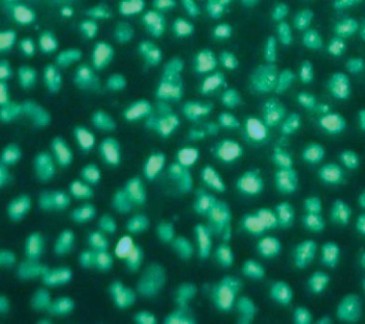
Graphic
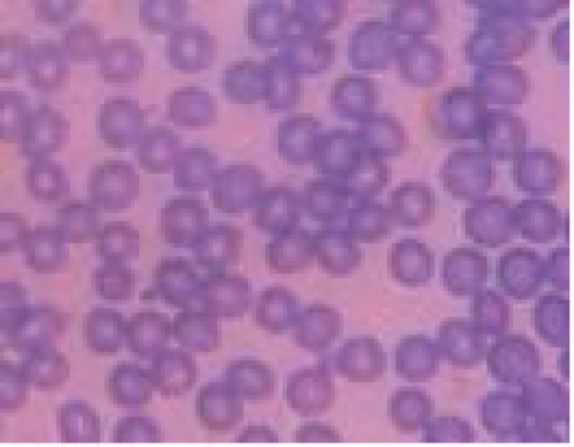
Graphic

于2023年5月11日提交给美国证券交易委员会
第333号注册-
美国
证券交易委员会
华盛顿特区20549
表格S-4
下的注册声明
1933年《证券法》
(注册人在其章程中指明的确切名称)
特拉华州 (国家或其他司法管辖权 |
|
6770 (初级标准工业 |
|
86-1963522 (国税局雇主 |
联邦街175号,875套房
马萨诸塞州波士顿02110
(617) 279-0045
(登记人主要行政办公室的地址,包括邮政编码和电话号码,包括区号)
Joel Shulman
首席执行官
Apeiron Capital Investment Corp.
联邦街175号,875套房
马萨诸塞州波士顿02110
(617) 279-0045
(服务代理人的姓名、地址,包括邮政编码和电话号码,包括区号)
副本:
Stuart Neuhauser,Esq。 |
|
迈克尔·J·布兰肯希普,彼岸。 Winston & Strawn LLP 国会街800号,套房2400 休斯敦,TX77002-2925 (713) 651-2600 |
建议向公众出售的大致开始日期:在(i)本登记声明宣布生效及(ii)所附代理声明/招股章程所述的适用交易完成后,在切实可行范围内尽快开始。
如果在本表格上登记的证券是与控股公司的成立有关的,并且符合一般指示G的规定,请选中以下方框:☐
如果根据《证券法》第462(b)条提交本表格,以便为一次发行登记更多证券,请选中以下方框,列出同一次发行的先前有效登记声明的《证券法》登记声明编号:☐
如果本表格是根据《证券法》第462(d)条提交的生效后修订,请选中以下方框,列出同一发行的较早生效登记声明的《证券法》登记声明编号:☐
通过复选标记指明注册人是大型加速申报人、加速申报人、非加速申报人还是较小的报告公司。参见《交易法》第12b-2条中“大型加速申报人”、“加速申报人”和“小型申报公司”的定义。
大型加速披露公司 |
☐ |
加速披露公司 |
☐ |
|
☒ |
规模较小的报告公司 |
|
新兴成长型公司 |
|
如果是一家新兴成长型公司,请勾选注册人是否选择不使用延长的过渡期来遵守《证券法》第7(a)(2)(B)节规定的任何新的或经修订的财务会计准则。☐
在适用的情况下,在方框中加上一个X,以指明在进行此项交易时所依赖的适当规则条文:
《交易法》第13e-4(i)条(跨境发行人要约收购)☐
《交易法》第14d-1(d)条(跨境第三方投标报价)☐
注册人特此在可能需要的一个或多个日期对本注册声明进行修订,以延迟其生效日期,直至注册人提交进一步的修订,其中明确规定本注册声明此后应根据经修订的1933年《证券法》第8(a)节生效,或直至注册声明在SEC根据第8(a)节确定的日期生效。
本初步代理声明/招股说明书中的信息不完整,可能会有所更改。在向证券交易委员会提交的注册声明(本代理声明/招股说明书是该声明的一部分)被宣布生效之前,注册人不得发行本初步代理声明/招股说明书所提供的证券。本初步代理声明/招股说明书不构成出售这些证券的要约,也不是在不允许提供或出售这些证券的任何司法管辖区征求购买这些证券的要约。
初步代理声明/展望—待完成,日期:2023年5月11日
PROXY STATEMENT FOR SPECIAL MEETING IN LIEU OF 2023 ANNUAL MEETING OF
股东
APEIRON CAPITAL INVESTMENT CORP。
我们诚挚地邀请你出席特拉华州公司Apeiron Capital Investment Corp.(ACIC)的2023年股东年会(“特别会议”),该年会实际上将于2023年东部时间[·]上午[·]举行,或在特别会议可能休会或延期的其他时间和日期举行。特别会议应被视为一次特别会议,以取代ACIC的2023年年度股东大会。特别会议将是一次通过网络直播进行的虚拟会议。您或您的代理人可以通过访问https://www.cstproxy.com/[·]并使用大陆证券转让信托公司指定的控制号码参加特别会议并在会上投票。注册股东和实益股东(通过银行、经纪人或其他代名人持有股份的股东)若要注册并获得参加虚拟会议的权限,需要遵循随附的代理声明/招股说明书中提供的适用于他们的指示。
2023年3月8日,ACIC与GIO World Health Limited(一家根据英格兰和威尔士法律成立的私人有限公司)、Apeiron Capital Sponsor,LLC(一家特拉华州有限责任公司)签订了《企业合并协议》(于2023年5月10日修订,并根据协议条款不时予以修订、重述或补充,简称《企业合并协议》),根据《企业合并协议》的条款和条件,在《企业合并协议》所设想的交易(“交割”)完成后,作为ACIC股东(卖方及其继承人和受让人除外)的代表,Deven Patel,作为根据《企业合并协议》的条款和条件的卖方代表(“卖方代表”),以及属于《企业合并协议》缔约方的GIO股东(无论是截至《企业合并协议》签署之日,还是随后根据合并协议加入的股东,即“卖方”),根据该协议,各方已同意完成《企业合并协议》中所述的交易,但须遵守协议的条款和条件(此类交易统称为“企业合并”)。
根据业务合并协议,卖方将根据协议中规定的条款和条件,向ACIC出售,ACIC将向卖方购买卖方拥有的GIO所有已发行和未发行的普通股(“已购买股份”),以换取ACIC新发行的A类普通股,每股面值0.0001美元(“ACIC A类普通股”)。任何GIO期权、认股权证和其他可转换证券在收盘前尚未转换为GIO普通股,将于收盘时终止。
根据业务合并协议的条款,ACIC在交割时向卖方交付的总对价(“交换对价”)将是ACIC新发行的A类普通股的数量,总价值为2.50亿美元乘以百分比,等于(i)已购买的股份总数除以(ii)GIO已发行和已发行的普通股总数加上GIO库存中持有的股本股份数量。GIO在交割后立即以库存形式持有的任何股本股份将由GIO注销。卖方目前是企业合并协议的一方,持有GIO已发行及已发行普通股的合计98.703%;预计其他GIO股东将在注册声明生效后但在企业合并完成日期(“截止日期”)之前签署合并协议,从而成为企业合并协议的一方。
除上述交易所对价外,根据业务合并协议的条款,如果某些指标在截止日期开始至截止日期五周年结束的期间内得到满足,某些卖方还将有权在收盘后获得最多54,000,000股ACIC A类普通股(“盈利股份”)。
预计在交易结束后,ACIC的公众股东将拥有合并后公司约5.1%的权益,保荐人将拥有约14.6%的权益,卖方将拥有合并后公司已发行股份总数的约80.3%。这些所有权百分比不考虑(i)ACIC公众股东赎回任何股份,(ii)持有人行使任何ACIC认股权证,或(iii)任何盈利股份的发行,还包括“股份计算和所有权百分比”和“未经审计的备考简明合并财务报表”中规定的假设。如果实际情况与这些假设(它们很可能是)不同,ACIC公众股东保留的所有权百分比将有所不同。见“股份计算和所有权百分比”和“未经审计的简明合并财务报表”。
合并完成后,ACIC将更名为“GIO World Health Holdings,Inc.”。我们将企业合并完成后的ACIC称为“合并后的公司”,将企业合并完成后的ACIC普通股称为“合并后的公司普通股”。ACIC单位、普通股和公开认股权证在OTC Markets Group Inc.(简称“OTCM”)的Pink Market交易,交易代码分别为“APNCU”、“APNC”和“APNCW”。2023年[·],ACIC单位、普通股和公开认股权证的收盘价分别为[·]美元、[·]美元和[·]美元。普通股在OTCM或国家证券交易所上市是收盘的一个条件。
只有在2023年[·](“记录日期”)营业时间结束时持有ACIC普通股股票记录的股东才有权获得特别会议通知和投票,并在特别会议和特别会议的任何休会期间计票。
随附的代理声明/招股说明书提供了有关业务合并和特别会议将审议的其他事项的详细信息。ACIC促请你仔细阅读这整个文件和在此引入的文件作为参考。您还应仔细考虑从随附的代理声明/招股说明书第53页开始的“风险因素”中描述的风险因素。
经过认真审议,ACIC董事会已批准了《企业合并协议》及其所设想的交易,并确定将在特别会议上提交的每一项提案都符合ACIC及其股东的最佳利益,并建议你投票或指示对每一项提案投“赞成”票。
ACIC董事和管理人员的财务和个人利益的存在可能导致利益冲突,包括在决定建议股东投票支持提案时,符合ACIC最佳利益的事项与符合董事个人利益的事项之间的冲突。有关进一步的讨论,请参阅随附的委托书/招股说明书中题为“提案1:企业合并提案—— ACIC的保荐人、董事和高级管理人员及其他人员在企业合并中的权益”和“证券的实益所有权”的章节。
你的投票很重要。为确保你在特别会议上有代表权,请按照随附的代理声明/招股说明书及代理卡上的指示填写并交回随附的代理卡,或提交代理卡。无论你是否打算参加会议,请立即提交你的代理。现在提交代理不会妨碍你在虚拟特别会议期间进行在线投票。如果你以“街道名称”持有你的股票,你应该指示你的银行、经纪人或其他代名人如何按照你从你的银行、经纪人或其他代名人那里收到的投票指示表格投票。
如果你返回你的代理卡签名,但没有表明你希望如何投票,你的股份将投票赞成每一个提案。
要行使您的赎回权,您必须(1)在行使您的赎回权之前,选择将您的股票单位分离成相关的公开股票和公开认股权证,如果您通过股票单位持有普通股,(2)在特别会议投票之前至少两个工作日向转让代理提交书面请求,您的公开In EACH CASE IN CORDANCE WITH THE PROCEDURES AND DEADLINES DESCRIBED IN THE ACCORDANCE IN THE PROCOMPANYING PROXY STATEMENT/PROSPECTUS。如果商业组合未被消费,则公众股份将不会被兑换为现金。如果你以街道名称持有股票,你需要指示你的银行、经纪人或其他被提名人从你的账户中提取股票,以便行使你的赎回权。有关更具体的说明,请参阅随附的代理声明/展望中的“股东特别会议——赎回权”。
本代理声明/招股说明书通过引用纳入了本代理声明/招股说明书中未包含或随附的文件中有关ACIC的重要商业和财务信息。您可以通过访问ACIC的网站www.sec.gov,或通过书面或电话向ACIC的代理律师[·] [·]索取这些文件,获取本代理声明/招股说明书和ACIC向美国证券交易委员会(“SEC”)提交的其他文件中以引用方式纳入的文件。你所要求的任何这些文件都不会向你收费。为及时交付文件,你方必须在特别会议日期前五个工作日内提出要求,或至迟于2023年[·]。
美国证券交易委员会和任何州证券委员会都没有批准或不批准根据随附的委托书/招股说明书发行的证券,也没有确定随附的委托书/招股说明书是准确或完整的。任何相反的陈述都是刑事犯罪。
随附的委托书/招股说明书的日期为2023年[·],将于2023年[·]前后首次邮寄给ACIC的股东。
APEIRON CAPITAL INVESTMENT CORP。
联邦街175号,875套房
马萨诸塞州波士顿02110
2023年度股东特别会议通知
将于2023年[·]举行
致APEIRON CAPITAL INVESTMENT CORP.股东:
特此通知,特拉华州公司Apeiron Capital Investment Corp.(ACIC)将于美国东部时间2023年[·]上午[·]举行一次特别会议,以代替2023年年度股东大会(“特别会议”)。特别会议将是一次通过网络直播进行的虚拟会议。您或您的代理人可以通过访问https://www.cstproxy.com/[·]并使用大陆证券转让信托公司指定的控制号码参加特别会议并在会上投票。特别会议将举行,目的是审议和表决下文和所附的代理声明/招股说明书中所述的提案。注册股东和实益股东(通过银行、经纪人或其他代名人持有股份的股东)若要注册并获得参加虚拟会议的权限,需要遵循随附的代理声明/招股说明书中提供的适用于他们的指示。你将不能通过只听形式投票或提交问题。
在特别会议上,将请你审议并表决下列提案:
| ● | 建议1 ——业务合并建议——核准企业合并协议及其所设想的交易的提案。 |
| ● | 提案2 — NTA提案—一项修改ACIC经修订和重述的公司注册证书的提案,取消了限制ACIC赎回A类普通股的能力的要求,并在此类赎回金额将导致ACIC的有形资产净值低于5,000,001美元的情况下完成初始业务合并。 |
| ● | 提案3 ——《宪章》提案——一项建议,就业务合并事宜批准经修订及重报的ACIC建议成立为法团的证明书拟议宪章”). |
| ● | 建议4 – 9 —组织文件建议—一项关于六项单独的不具约束力的咨询建议的建议,假定业务合并建议获得核准和通过,则应核准现行《宪章》与拟议《宪章》之间的重大差异。 |
| ● | 建议10 ——激励计划建议——批准GIO World Health Holdings,Inc. 2023股权激励计划的提案。 |
| ● | 提案11 — 董事选举提案—批准选举七名董事进入合并后的公司董事会的提案。 |
| ● | 提案12----休会提案---提议将特别会议推迟到一个或多个必要或适当的日期,由行政协调会理事会决定。 |
在特别会议上提交表决的提案在随附的代理声明/招股说明书中有更全面的描述,其中还包括作为附件A的《企业合并协议》的副本。咨询委员会促请你仔细阅读随附的代理声明/招股说明书全文,包括附件和随附的财务报表。
经认真审议后,ACIC董事会已批准了《企业合并协议》及其所设想的交易,并确定将在特别会议上提交的每一项提案都符合ACIC及其股东的最佳利益,并建议你投票或指示对上述每一项提案投“赞成”票。
ACIC董事和管理人员的财务和个人利益的存在可能导致利益冲突,包括在决定建议股东投票支持提案时,符合ACIC最佳利益的事项与符合董事个人利益的事项之间的冲突。有关进一步的讨论,请参阅随附的委托书/招股说明书中题为“提案1:企业合并提案—— ACIC的保荐人、董事和高级管理人员及其他人员在企业合并中的权益”和“证券的实益所有权”的章节。
特别会议的记录日期是2023年[·]。只有在记录日期营业时间结束时持有ACIC普通股记录的股东才有权获得特别会议的通知和投票,并在特别会议和特别会议的任何休会期间对其投票进行统计。
ACIC单位、普通股和公开认股权证在场外交易市场的交易代码分别为“APNCU”、“APNC”和“APNCW”。2023年[·],ACIC单位、普通股和购买ACIC普通股的认股权证(简称“ACIC认股权证”)的收盘价分别为[·]美元、[·]美元和[·]美元。合并后的公司拟申请将其股票和认股权证在OTCM或全国性证券交易所上市,股票代码分别为“[·]”和“[·]”。普通股在场外交易市场或国家证券交易所上市是收盘的条件。无法保证合并后的公司能够满足初始上市要求或在业务合并完成后继续上市的要求。
根据现行章程,已发行的ACIC A类股票(“公众股”和“公众股东”)的持有人可要求ACIC在企业合并完成后将其全部或部分公众股赎回为现金。只有在以下情况下,你方有权获得赎回任何公众股份的现金:
| a) | 持有公众股份或透过ACIC单位持有公众股份,而你在行使有关公众股份的赎回权前,选择将你的ACIC单位分离为基础公众股份及认股权证;及 |
| b) | 美国东部时间下午5时前,在[·]、2023年(特别会议投票前两个工作日)(或ACIC自行决定批准的较后日期),(i)向转让代理提交书面请求,要求ACIC以现金赎回您的公众股份,以及(ii)通过DTC以实物或电子方式将您的股票证书(如有)和其他赎回表格交付给转让代理。 |
ACIC单位的持有人在行使公众股份的赎回权之前,必须选择分离基础股份和认股权证。持有人可以指示其银行、经纪人或其他代名人这样做,或者,如果持有人持有以自己的名义注册的ACIC单位,持有人必须直接与转让代理人联系并指示其这样做。
公众股东可以选择赎回其全部或部分公众股份,无论他们是否投票赞成或反对企业合并提案。如果企业合并未完成,公众股份将不会被赎回为现金。如果公众股东正确行使其赎回其公众股份的权利,并及时将其股票(如果有的话)和其他赎回表格交付给转让代理,ACIC将以每股现金支付的价格赎回每一股公众股份,该价格等于在ACIC首次公开发行(IPO)相关的信托账户(“信托账户”)中存入的总金额,该金额在企业合并完成前两个工作日计算,包括以前没有交给ACIC缴税的信托账户中的资金所赚取的利息,除以当时已发行的公众股份的数量。截至2023年[·],这一数额约为每股公股[·]美元。如果公众股东行使其赎回权,它将以该股东的公众股份换取该股东按比例获得信托账户份额的权利,并且将不再拥有该公众股份。任何赎回要求一经提出,可随时撤回,直至要求赎回的截止日期,其后经ACIC同意,直至企业合并完成,或ACIC董事会确定的其他日期。股东可以通过在随附的代理声明/招股说明书中列出的地址或电子邮件地址联系转让代理提出此类请求。请参阅随附的代理声明/招股说明书中的“股东特别会议——赎回权”,详细说明如果您希望用现金赎回您的公众股份,应遵循的程序。
尽管有上述规定,公众股东,连同该公众股东的任何附属机构或与该公众股东一致行动的任何其他人,或作为一个“团体”(定义见经修订的1934年美国证券交易法第13条),将被限制赎回其公众股份,不得超过公众股份总数的15%。因此,如果公众股东单独或一致行动或作为一个集团寻求赎回超过15%的公众股份,则超过15%限制的任何此类股份将不会被赎回为现金。
企业合并提案、章程提案、激励计划提案和董事选举提案(“必要提案”)是相互依存的。组织文件提案以所需提案为条件。NTA提案的条件是业务合并提案获得批准。因此,如果企业合并提案未获批准,那么NTA提案即使获得股东批准也不会产生任何效果。暂停提案不以核准任何其他提案为条件。如果ACIC的股东没有在特别会议上批准每一项必要的提案,那么企业合并将无法完成。
除NTA提案、章程提案、组织文件提案和董事选举提案外,每一项提案都需要获得在特别会议上投票的ACIC普通股多数股东的赞成票。
NTA提案要求持有ACIC普通股多数流通股的股东投赞成票。
章程提案要求获得ACIC普通股已发行股份多数股东(包括B类股份多数股东,作为单独类别投票)的赞成票。每一项组织文件提案都需要获得ACIC普通股已发行股票多数持有者的赞成票。
董事选举提案要求出席特别会议或由代表出席特别会议的ACIC普通股股东的多数票。“多元化”指的是,获得“赞成”票数最多的个人当选为董事。
请注意本通知所附的代理声明/招股说明书(包括其附件),以便更全面地说明拟议的业务合并和相关交易以及每项建议。ACIC敦促您仔细阅读随附的代理声明/招股说明书。
如果您有任何问题或需要协助投票表决您的普通股,请联系ACIC的代理律师,[·]免费电话[·](银行、经纪人和其他代名人致电[·]),或发送电子邮件[·]。这份特别会议通知和代理声明/招股说明书可在美国证交会网站www.sec.gov上查阅。
由行政协调会董事会命令 |
|
Joel Shulman |
|
董事会主席 |
补充资料
随附的文件是ACIC的证券招股说明书。根据经修订的1934年《美国证券交易法》(《交易法》)第14(a)节,本文件还构成一份会议通知和一份代理声明,内容涉及ACIC特别会议,在该会议上,ACIC股东将被要求审议一项通过批准和通过《企业合并协议》批准企业合并的提案,并对该提案进行表决。ACIC的股东可根据书面或口头请求免费获得随附的代理声明/招股说明书。本文件和ACIC向美国证券交易委员会(SEC)提交的其他文件可通过书面或口头请求向ACIC首席执行官Joel Shulman博士索取,地址为Apeiron Capital Investment Corp.,地址为:Federal Street 175,Suite 875,Boston,Massachusetts 02110,或致电(617)279-0045。为及时交付文件,你方必须在特别会议日期前五个工作日内提出要求,或至迟于2023年[·]。
SEC拥有一个网站,其中包含报告、代理声明和信息声明,以及以电子方式向SEC提交的有关发行人的其他信息。您可以在SEC的网站www.sec.gov上获得上述材料的副本。
此外,如果您对提案或随附的代理声明/招股说明书有任何疑问,想要随附的代理声明/招股说明书的其他副本,或需要获取代理卡或与代理招标有关的其他信息,请联系ACIC的代理律师[·],地址为[·]。你所要求的任何文件都不会向你收费。
有关更多信息,请参阅随附的代理声明/招股说明书中题为“在哪里可以找到更多信息”的部分。
GIO网站上所载或可通过GIO网站查阅的信息不作为参考纳入所附的代理声明/招股说明书。
目 录
|
页 |
|
9 |
||
15 |
||
15 |
||
15 |
||
19 |
||
36 |
||
49 |
||
50 |
||
52 |
||
53 |
||
118 |
||
119 |
||
121 |
||
127 |
||
159 |
||
160 |
||
165 |
||
168 |
||
175 |
||
176 |
||
177 |
||
182 |
||
183 |
||
184 |
||
190 |
||
194 |
||
Management’s Discussion and Analysis of FINANCIAL CONDITION AND RESULTS OF OPERATION OF ACIC |
199 |
|
202 |
||
229 |
||
230 |
||
230 |
||
230 |
||
MANAGEMENT’s DISCUSSION ANALYSIS OF FINANCIAL CONDITION AND RESULTS OF OPERATIONS OF GIO |
231 |
|
MANAGEMENT OF THE COMBINED COMPANY FLLOWING THE BUSINESS COMBINATION |
236 |
|
240 |
||
242 |
||
245 |
||
248 |
||
253 |
||
253 |
||
253 |
||
253 |
||
253 |
||
254 |
||
254 |
||
254 |
||
F-1 |
||
A-1 |
||
A-2-1 |
||
附件B ——拟议章程 |
B-1 |
|
附件C —拟议的附例 |
C-1 |
|
D-1 |
||
E-1 |
介绍和词汇的基础
常用术语
如本委托书/招股说明书所用,除非另有说明或上下文另有要求:
“行政支持协议”是指发起人与ACIC于11月8日签署的行政支持协议。
“ACIC董事会”是指ACIC的董事会。
“ACIC普通股”或“普通股”是指ACIC的普通股,每股面值0.0001美元,这些股份将拥有权利和优先权,否则将受《现行章程》规定的条款和条件的约束。
“ACIC股东批准”是指根据ACIC的组织文件、适用法律和本委托书/招股说明书,由ACIC股东在特别会议上以必要的投票方式批准所需提案。
“ACIC单位”是指ACIC根据《现行章程》规定的条款发行的单位,每一单位由一股普通股和一份半份认股权证(每份整份认股权证赋予其持有人购买一股普通股的权利)组成。
“ACIC”指的是Apeiron Capital Investment Corp.,该公司将在交易结束后更名为“GIO世界健康控股公司”。
“附属协议”是指根据企业合并协议订立或将订立的其他协议。
“附属文件”指作为证物附上的每一份协议、文书或文件,以及企业合并协议的任何一方就企业合并协议或根据企业合并协议签署或交付的其他协议、证书和文书。
“业务合并协议”指由ACIC、GIO、买方代表、卖方和卖方代表根据协议条款不时修订、重述或补充的业务合并协议。业务合并协议的副本作为附件A附于本委托书/招股说明书之后。
“企业合并”是指企业合并协议所设想的交易。
“Cantor”指的是Cantor Fitzgerald & Co。
“A类股份”是指公众股份。
“B类股份”指的是创始人股份。
“结束”是指企业合并的结束。
“交割日期”是指交割发生的日期。
“法典”指的是经修订的1986年《国内税收法》。
“合并后的公司”是指GIO World Health Holdings,Inc.,在业务合并完成后将成为ACIC的名称。
“合并后的公司董事会”是指合并后公司的董事会。
9
“合并公司普通股”是指合并后公司的普通股,每股面值0.0001美元,以及在收盘后作为股息或分配支付的股票,或在收盘后交换或转换成的股票。
“Continental”指的是Continental Stock Transfer & Trust Company。
“现行章程”是指经修订的ACIC经修订和重述的公司注册证书。
“DGCL”指的是经修订的《特拉华州一般公司法》。
DTC的意思是存款信托公司。
DWAC是指DTC在托管系统中的出入金。
“盈利卖方”是指某些有权在收盘后获得盈利股票的卖方。
“盈利股份”是指在盈利期间满足某些指标的情况下,可向盈利卖方发行的合并公司普通股的额外股份,金额不超过54,000,000股乘以所购股份百分比。
“生效时间”是指企业合并按照企业合并协议的条款完成的日期和时间。
“交易法”是指经修订的1934年美国证券交易法。
“EverEdge”或“公平意见提供者”是指EverEdge Global Ltd.。
“交换对价”是指就企业合并向卖方交付的对价将是ACIC A类普通股的新发行数量,总价值为2.50亿美元乘以百分比,等于(i)购买的股份总数除以(ii)GIO在交割前已发行和流通的股本总数加上GIO在库存中持有的股本股份数量。
“交易所股票”是指在收盘时向卖方发行的ACIC A类普通股的总数。
“延期”是指延长ACIC必须按照现行章程的条款完成其业务合并的最后期限。
“FINRA”是指金融业监管局。
“创始人股份”是指在首次公开发行前,由保荐人在一次私募中购买的,由保荐人持有的普通股。
“GAAP”指的是美国公认会计原则。
“GIO”是指GIO世界健康有限公司,一家根据英格兰和威尔士法律成立的私人有限公司。
“GIOSTAR”指的是全球干细胞治疗研究所。
“激励计划”是指将由ACIC董事会通过的GIO World Health Holdings,Inc. 2023股权激励计划,但须经ACIC股东特别会议批准,其形式作为附件D附于本委托书/招股说明书,详见本委托书/招股说明书的“激励计划提案”部分。
“内部人信函协议”是指ACIC与每一位内部人于2021年11月8日签署的信函协议。
10
“内幕信息知情人登记权协议”指ACIC、保荐人和Cantor于2021年11月8日就首次公开发行签订的《登记和股东权利协议》,该协议根据其条款不时修订。
“内部人”指的是在首次公开发行时,ACIC的高级管理人员和董事、保荐人以及方正股份的每一位受让人。
“过渡期”是指自企业合并协议之日起,一直持续到企业合并协议终止或交易结束之日(以较早者为准)的期间。
“IPO招股说明书”是指ACIC的最终招股说明书,日期为2021年11月8日,于2021年11月10日提交给美国证券交易委员会(文件编号:333-257369)。
“首次公开发行”是指ACIC根据IPO招股说明书对其单位、普通股和认股权证进行的首次公开发行。
“投资公司法”是指经修正的1940年《投资公司法》
“JOBS法案”指的是《创业启动法案》。
“锁定协议”是指在《企业合并协议》之前或同时签订的协议,根据这些协议,某些GIO股东同意根据《企业合并协议》的条款,对在交割时向其发行的ACIC普通股的交割后转让作出某些限制。
“非竞争协议”是指ACIC和某些GIO股东根据业务合并协议的条款在交割前以及作为交割条件而订立的非竞争协议和非招揽协议。
“私人认股权证”是指在首次公开发行时,ACIC以私募方式向保荐人和Cantor发行的购买普通股的认股权证,每份认股权证的持有人有权以每股11.50美元的价格购买一股普通股。
“提案”是指在特别会议上提交给ACIC股东的所有提案。
“拟议章程”是指合并后公司的经修订和重述的章程,其格式载于本委托书/招股说明书附件C,拟于交割时及交割后生效,详见本委托书/招股说明书“章程建议书”部分。
“拟议章程”是指合并后公司的经修订和重述的公司注册证书,其格式为本委托书/招股说明书附件B,拟于交割时及交割后生效。
“公众股”是指在IPO中出售的A类普通股(包括ACIC承销商获得的超额配售单位中包含的普通股),无论它们是在IPO中购买的,还是随后在公开市场上购买的。
“公众股东”是指在相关日期持有公众股份的股东。
“公开认股权证”是指最初作为公共单位的一部分包含的认股权证,该认股权证的持有者有权以每股11.50美元的价格购买一股普通股。
“购买股份百分比”是指价值2.50亿美元乘以一个百分比,等于(i)购买股份总数除以(ii)GIO在收盘前已发行和流通股本的总数加上GIO库存股本的数量。
“购买的股份”是指卖方拥有的GIO的所有普通股,卖方将出售给ACIC,ACIC将从卖方购买。
“买方代表”是指Apeiron Capital保荐人有限责任公司,在生效时间之前的ACIC股东(GIO权益的前股东除外)的生效时间和之后作为代表。
11
“记录日期”指[·],2023年。
“赎回日期”是指公司可根据现行章程赎回选举公众股东的公众股份的截止日期。
“赎回价格”是指在适用的赎回日,根据现行章程计算的金额,等于当时存入信托账户的总金额的按比例部分。
“赎回”是指以赎回价格赎回公众股份。
“必要提案”是指企业合并提案、章程提案、激励计划提案和董事选举提案。
“SEC”指的是美国证券交易委员会。
《证券法》是指经修订的1933年《证券法》。
“卖方代表”指Deven Patel,根据业务合并协议的条款和条件,以卖方代表的身份。
“卖方”是指作为企业合并协议当事方的GIO股东(无论是在企业合并协议签署之日,还是随后根据合并协议加入的股东)。
“签署日期”是指企业合并协议的执行日期。
“特别会议”是指代替2023年ACIC股东年会召开的与企业合并相关的特别会议,在该会议上,ACIC股东将被要求审议并投票表决一项提案,以通过和批准《企业合并协议》及其所设想的交易。
“赞助商”指Apeiron Capital赞助商有限责任公司,一家特拉华州有限责任公司。
“交易融资”是指ACIC在企业合并协议签署至交割期间订立的任何股权或债务融资协议所设想的融资。
“转让代理”指的是大陆股票转让信托公司。
“治疗”是指基于干细胞和干细胞的产品、疗法、治疗、服务、程序、技术、方案或其他产品,这些产品可能随时或不时成为未来业务线的一部分。
“触发事件”是指在盈利期内,Earnout股票可向Earnout卖方发行的任何指标的满足度。
“信托账户”是指ACIC根据《信托协议》根据《首次公开发行说明书》使用首次公开发行和出售私人认股权证所得款项设立的信托账户。
“信托协议”指ACIC与受托人于2021年11月8日签署的投资管理信托协议,以及与信托账户相关或管辖信托账户的任何其他协议。
“受托人”是指大陆证券股份转让信托公司,根据信托协议,该公司是受托人。
“通用红细胞”是指O型阴性红细胞。
“投票协议”是指ACIC、GIO和某些GIO股东在企业合并协议执行时或之前签订并交付给ACIC的投票协议。
12
就任何证券而言,“VWAP”是指在纽约时间上午9:30:01开始至纽约时间下午4:00结束期间,该证券在纽约时间上午9:30:01开始至纽约时间下午4:00结束的主要证券交易所或证券市场上的美元成交量加权平均价格,如彭博通过其“惠普”功能(设为加权平均)报告,或在不适用上述规定的情况下,该证券在纽约时间上午9:30:01开始的期间,在该证券的电子公告板上的场外市场上的美元成交量加权平均价格,并在纽约时间下午4:00:00结束,如彭博报道,或如彭博在该时段内没有报告此类证券的美元成交量加权平均价格,则为OTC Markets Group Inc.报告的此类证券的任何做市商的最高收盘价和最低收盘价的平均值。如果无法根据上述任何一种基准在该日期计算此类证券的VWAP,该证券在该日期的VWAP,应是由适用发行人的董事会(或同等理事机构)中的多数无私独立董事合理和善意地确定的公允市场价值。在此期间,所有这些决定都应针对任何股票股息、股票分割、股票合并、资本重组或其他类似交易进行适当调整。
“认股权证协议”是指ACIC与大陆集团于2021年11月8日签署的认股权证协议,该协议管辖ACIC的未行使认股权证。
“认股权证”是指私人认股权证和公开认股权证的统称。
13
股份计算和所有权百分比
除非另有说明(包括在题为“未经审计的合并财务资料”和“证券的实益所有权”的章节中),本代理声明/招股说明书中关于合并后公司股东的股份计算和所有权百分比仅用于说明目的,并假定如下(以下某些大写术语在本代理声明/招股说明书的其他地方定义):
| 1. | 没有任何公众股东在收盘时行使其赎回权。请参阅题为"特别会议----赎回权。” |
| 2. | 在截止日期或之前,保荐人没有转让所持证券。 |
| 3. | ACIC认股权证的持有人均不行使任何未行使的ACIC认股权证。 |
| 4. | 截止日期前GIO的资本没有变化。 |
| 5. | 在截止日期前,截至业务合并协议签立之日尚未签立的所有卖方签署日期“)签署并交付合并协议,以便在签署日期之后和截止日期之前成为合并协议的当事方,以便在交割时和为交割的目的,根据业务合并协议的条款,所有已发行的GIO普通股均为”购买的股份"。 |
| 6. | 为计算在交易结束后立即进行的预估所有权,在符合本文进一步说明的假设的前提下,并酌情在本委托书/招股说明书的预估财务报表章节中,业务合并完成后的假定赎回价格为10.47美元,这是根据截至2023年4月30日信托账户的金额计算的,不包括2023年3月31日之后信托账户资金赚取的任何利息。 |
| 7. | 在交割时,ACIC将以现金方式向保荐人的关联公司偿还由ACIC于2023年4月5日发行的无息本票下的全部未偿金额,本金为25万美元,涉及该关联公司向ACIC提供的贷款,以根据票据条款为ACIC的延期付款提供资金。 |
| 8. | 不发行盈利股票。 |
| 9. | 在交割时以交换对价交换的已购买股份的总数是在签署日期签署业务合并协议的卖方所持有的股份(尽管GIO的其他股东可以通过在登记声明生效后签署合并协议,在交割前成为业务合并协议的一方)。 |
14
商标
本委托书/招股说明书还载有其他公司的商标、服务标志、商号和版权,这些都是它们各自所有者的财产。商标和服务标志在本文中统称为“商标”。
仅为方便起见,本代理声明/招股说明书中提及的商标和商品名称可能不带®或™符号,但此类引用无意以任何方式表明,根据适用法律,我们不会在最大程度上主张我们的权利或适用许可人对这些商标和商品名称的权利。
市场和行业数据
本委托书/招股说明书载有从第三方来源获得的市场和行业数据、估计数和统计数据。尽管ACIC和GIO都认为,这些公司对行业地位和行业数据的估计所依据的信息总体上是可靠的,但这些信息的准确性和完整性并不能得到保证,它们没有独立地核实来自第三方来源的任何数据,也没有确定其中所依据的基本经济假设。ACIC和GIO的公司内部报告未经任何独立消息来源核实。关于行业地位的声明是根据目前可获得的市场数据作出的。虽然ACIC和GIO并未发现与本文所述行业数据有关的任何错误陈述,但这些估计涉及风险和不确定性,可能会因各种因素而发生变化,包括本代理声明/招股说明书中在“风险因素”标题下讨论的因素。
关于前瞻性陈述的注意事项
本代理声明/招股说明书中的某些陈述可能构成1995年《美国私人证券诉讼改革法案》“安全港”条款所指的“前瞻性陈述”。这包括但不限于关于GIO未来业务的财务状况、业务战略以及管理计划和目标的说明,包括与潜在业务合并有关的说明。这些陈述是预测、预测和前瞻性陈述,并不是业绩的保证。这种说法可以通过它们与历史或当前事实并不完全相关这一事实来确定。在本委托书/招股说明书中,前瞻性陈述可以通过使用诸如“估计”、“继续”、“可能”、“可能”、“可能”、“可能”、“预测”、“应该”、“将”、“计划”、“项目”、“预测”、“打算”、“将”、“预期”、“预期”、“相信”、“寻求”、“目标”、“旨在”或其他类似的表达方式来识别,这些表达方式预测或指示未来的事件或趋势,或者不是对历史事实的陈述。此外,任何涉及对未来事件或情况的预测、预测或其他特征的陈述,包括任何基本假设,都是前瞻性陈述。
ACIC提醒代理声明/招股说明书的读者,这些前瞻性陈述存在风险和不确定性,其中大部分难以预测,许多超出了ACIC和GIO的控制范围,可能导致实际结果与预期结果存在重大差异。这些前瞻性陈述包括但不限于关于预期事件或情况、业务计划或目标、预测结果、市场机会预测、潜在利益和GIO产品和服务对客户的潜在商业吸引力、GIO管理层期望追求的业务和业务线的潜在成功、业务合并的潜在利益(包括股东价值)以及与业务合并的条款和时间有关的预期。这些陈述是基于各种假设,无论是否在本代理声明/招股说明书中确定,以及GIO管理层目前的期望,而不是对实际业绩的预测。这些前瞻性陈述仅用于说明目的,并不是作为保证、保证、预测或对事实或可能性的明确陈述,任何投资者也不得依赖这些陈述。实际事件和情况很难或不可能预测,而且会与假设不同。这些前瞻性陈述受到一些风险和不确定性的影响,包括:对GIO业务战略的预期(以及GIO达到预期的能力),对未来业务活动和业务线的计划,以及未来的财务业绩,包括GIO的未来业务计划或目标,监管机构批准或接受未来可能寻求监管机构批准的产品或技术的结果或时间,对其产品的预期需求和接受,定价,营销计划,制造,生产和供应能力,运营费用,市场趋势,收入,流动性,获得资金的渠道,现金流动和现金使用、资本支出以及GIO投资于其可能希望或需要开展的活动的能力,以建立、维持或执行其业务计划或GIO管理层预期发展的业务领域;
| ● | 影响GIO可能建立和发展业务线的市场的规模和条件; |
| ● | GIO就GIO作为一个实体迄今尚未开始的业务部门制定和执行管理计划的能力; |
15
| ● | 由于GIO的业务计划的制定和实施方式,在无法获得其无法获得的大量资源的情况下,GIO可能无法准备或无法应对,因此可能会出现意料之外的风险、挑战和费用; |
| ● | GIO成功地开发了基于干细胞的产品和服务,并酌情获得监管或营销批准,以便在其可能希望销售或提供此类产品和服务的法域将此类产品或服务商业化; |
| ● | GIO在确定客户和开展合作以建立和开展某些预期的业务部门活动方面取得的成功; |
| ● | GIO吸引开展业务活动所需资金的能力; |
| ● | GIO产品、服务或技术未能按照GIO预期的方式或时间表开发,可能是由于GIO无法预见或无法控制的原因; |
| ● | 中断或停止GIO与其附属机构或GIO管理层附属机构的关系,这可能是GIO建立、发展或在其计划的业务领域取得成功所必需的; |
| ● | 适用法律法规的变化以及GIO遵守这些法规的能力; |
| ● | 未来相关地区市场对基于干细胞的产品和服务的接受度可能下降或发生不利变化,或无法增长的风险; |
| ● | 对GIO业务前景和潜在财务业绩的估计可能与实际结果存在重大差异; |
| ● | 竞争对GIO未来业务的影响; |
| ● | 与旨在证明GIO将为其预期目的提供的产品或服务的功效的临床、安全和其他测试、试验或研究的结果不确定有关的风险; |
| ● | 任何可能延误业务合并或导致终止业务合并协议的事件、变更或其他情况的发生; |
| ● | 在宣布企业合并协议及其所设想的交易后,可能对ACIC、GIO和其他人提起的任何法律诉讼的结果; |
| ● | 由于未能获得ACIC股东批准或未能满足根据企业合并协议完成交易的其他条件而无法完成企业合并; |
| ● | GIO可能无法充分保护其使用或利用商业秘密、专有技术和其他知识产权的权利或能力的风险; |
| ● | 由于业务合并的宣布和完成,拟议的业务合并扰乱GIO目前建立其业务的计划的风险; |
| ● | 与拟议业务合并有关的费用; |
| ● | ACIC股东的赎回导致企业合并向GIO提供的收益可能低于GIO管理层的预期; |
| ● | New GIO证券的流动性和交易受限,且New GIO的证券不具备在全国性证券交易所上市的资格; |
| ● | 地缘政治风险和适用法律或条例的变化; |
16
| ● | GIO有能力在必要时以合理条款筹集资金,以便在GIO管理层预期的时间表内开发其产品和服务; |
| ● | 有能力在必要时成功获得市场营销和监管批准,以开展计划中的业务活动; |
| ● | ACIC或GIO可能受到其他经济、商业或竞争因素的不利影响; |
| ● | 新冠疫情或另一种重大疾病或流行病扰乱GIO业务的可能性; |
| ● | 当事人在各自完成对对方的尽职调查时发现的事项; |
| ● | 完成业务合并后,GIO未能吸引、留住、留住、激励或整合包括高技能科技人员在内的人员,或未能保持和发展良好的商业信誉,从而对其业务产生负面影响的风险; |
| ● | 诉讼和监管执行风险,包括管理时间和注意力的转移,以及对GIO资源的额外成本和需求; |
| ● | 业务合并的完成被大幅延迟或没有发生的风险,这可能影响GIO开始业务线运营或执行业务计划的能力; |
| ● | GIO应对总体经济状况的能力; |
| ● | 对未来运营和财务业绩及增长的预期,包括GIO预计何时能从业务运营中产生收入和正现金流; |
| ● | GIO执行其预期业务计划和业务线战略的能力; |
| ● | GIO持续遵守各项监管要求的能力; |
| ● | GIO在现有和新的市场和产品中与竞争对手竞争的能力; |
| ● | 未能满足完成企业合并的条件,包括ACIC股东对企业合并的批准和企业合并的最终协议;以及 |
| ● | 可能导致企业合并终止的任何事件、变更或其他情况的发生; |
| ● | 可能对GIO或ACIC提起的与企业合并相关的法律诉讼的结果,以及ACIC在IPO招股说明书中“风险因素”标题下讨论的因素,以及ACIC向SEC提交或将提交的其他文件;以及 |
| ● | 本委托书/招股说明书中描述的其他风险和不确定性,包括标题为“风险因素”一节下的风险和不确定性。 |
17
如果这些风险中的任何一个成为现实,或者ACIC或GIO的任何假设被证明是错误的,那么实际结果可能与这些前瞻性陈述所暗示的结果存在重大差异。可能存在ACIC和GIO目前都不知道或ACIC和GIO目前认为无关紧要的额外风险,这些风险也可能导致实际结果与前瞻性陈述中包含的结果存在重大差异。此外,前瞻性陈述反映了ACIC和GIO对未来事件的预期、计划或预测,以及截至本委托书/招股说明书发布之日的观点。ACIC和GIO预计,后续事件和发展可能会导致ACIC和GIO的评估发生变化。然而,尽管我们可能会选择在未来某个时候更新这些前瞻性陈述,但ACIC和GIO明确表示不承担这样做的义务。这些前瞻性陈述不应被视为代表ACIC和GIO在本代理声明/招股说明书日期之后的任何日期的评估。因此,不应过分依赖前瞻性陈述。实际结果、业绩或成就可能而且很可能与任何预测和前瞻性陈述以及这些前瞻性陈述所依据的假设存在重大差异,并可能产生不利影响。不能保证本文所包含的数据在任何程度上都反映了未来的表现。请注意不要过分依赖前瞻性陈述作为未来业绩的预测指标,因为预测的财务信息和其他信息所基于的估计和假设本身就受到各种重大风险、不确定性和其他因素的影响,其中许多因素超出了ACIC和GIO的控制范围。前瞻性陈述不能保证业绩。所有可归因于ACIC或GIO或代表他们行事的人的前瞻性陈述,其全部内容都受到上述警示性陈述的明确限定。除适用法律或法规要求的范围外,ACIC和GIO均不承担更新这些前瞻性陈述以反映本代理声明/招股说明书日期之后的事件或情况或反映意外事件的发生的任何义务。
18
问答
以下问题和答复简要阐述了关于拟在特别会议上提出的提案的一些常见问题,包括业务合并提案。以下问答并不包括对ACIC股东重要的所有信息。我们敦促ACIC的股东仔细阅读这份完整的委托书/招股说明书,包括其中提到的附件和其他文件。
问:为什么我会收到这份委托书/招股说明书?
答: |
你收到这份与ACIC股东特别会议有关的代理声明/招股说明书。行政协调会将举行特别会议,审议和表决本文件所述各项提案。你的投票很重要。我们鼓励你在仔细审阅这份委托书/招股说明书后尽快投票。 |
19
建议4
提议批准拟议章程中的规定,规定董事只能因故被免职,而且必须由至少66名董事的持有人投赞成票2/3合并后公司所有当时仍未发行的股票的投票权的%,这些股票在选举董事时有权普遍投票,作为一个单一类别一起投票。
建议5
建议批准拟议章程中的条文,规定(i)股东特别会议只能由合并公司董事会(定义见下文)根据合并公司董事会或合并公司秘书多数通过的决议,在收到股东的一份或多份书面要求召开股东特别会议后,合并公司董事会或合并公司秘书收到股东的书面要求,合并后公司已发行股份的至少25%的投票权和(ii)股东只能在年度会议和特别会议上采取行动,而不是通过书面同意。
建议6
建议批准《拟议章程》的条文,规定修订《拟议章程》的某些条文与董事人数和董事任期有关,以及任何修订《拟议章程》须获得至少66名股东的赞成票2∕3有权就该修正案投票的合并公司当时已发行的股本股份的投票权的百分比。
提议7
提议批准拟议章程中的条款,将合并后公司的公司名称改为“GIO World Health Holdings,Inc.”。
提议8
提议批准拟议章程中的条款,以删除与ACIC作为空白支票公司的地位有关的某些条款,这些条款在业务合并完成后将不再适用。
提议9
提议批准《拟议章程》中的规定,将各类股票的授权股份总数增加到260,000,000股,每股面值为0.0001美元,包括(i)250,000,000股普通股和(ii)10,000,000股优先股。
组织文件提案在随附的代理声明/招股说明书“提案4 – 9:组织文件提案”标题下有更详细的描述。]
(10)提案10 ——激励计划提案——批准GIO World Health Holdings,Inc. 2023股权激励计划的提案,简称“激励计划”,其形式作为附件D附在随附的委托书/招股说明书之后。ACIC董事会打算通过该激励计划,但须获得ACIC股东的批准。如果获得通过和核准,奖励计划将在结束时生效。激励计划提案在随附的委托书/招股说明书的标题“提案10:激励计划提案”下有更详细的描述。
(11)提案11 ——董事选举提案——关于批准选举七名董事进入合并公司董事会的提案,其中多数董事将是独立董事,包括GIO在交割前指定的五名董事和ACIC在交割前指定的两名董事,自交割时起生效,在合并公司董事会任职,直至其各自的继任者根据拟议章程的条款被正式选出并符合资格。董事选举提案在随附的代理声明/招股说明书的标题“提案11:董事选举提案”下有更详细的描述。
(12)提案12 ——休会提案——根据行政协调会理事会的决定,在必要或适当的情况下,将特别会议推迟到一个或多个日期举行的提案。这一提案被称为“休会提案”。这
20
延期提议在随附的代理声明/招股说明书的标题“提议12:延期提议”下有更详细的描述。
所需提案是相互依存的。组织文件提案以业务合并提案为条件。暂停提案不以核准任何其他提案为条件。如果ACIC的股东没有在特别会议上批准每一项必要的提案,那么企业合并将无法完成。
除NTA提案、章程提案、组织文件提案和董事选举提案外,每一项提案都需要获得在特别会议上投票的ACIC普通股多数股东的赞成票。
NTA提案要求持有ACIC普通股多数流通股的股东投赞成票。
章程提案要求获得ACIC普通股已发行股份多数股东(包括B类股份多数股东,作为单独类别投票)的赞成票。每一项组织文件提案都需要获得ACIC普通股已发行股票多数持有者的赞成票。
董事选举提案要求出席特别会议或由代表出席特别会议的ACIC普通股股东的多数票。“多元化”指的是,获得“赞成”票数最多的个人当选为董事。
问:ACIC的内部人士对企业合并有什么兴趣?
答: |
在考虑ACIC董事会对企业合并投赞成票的建议时,公众股东应该意识到,ACIC的内部人士在企业合并中拥有的利益与ACIC的公众股东的利益不同或不同。ACIC的董事在评估企业合并以及向ACIC的股东建议他们批准企业合并时,都意识到并考虑了这些利益。公众股东在决定是否批准企业合并时应考虑到这些利益。除其他外,这些利益包括: |
| ● | 保荐人持有4312500股创始人股份,这些股份是以25000美元的总价从ACIC购买的,如果合并完成,这些股份在合并时的价值会高得多,而根据2023年5月9日普通股的收盘价10.50美元计算,截至同一日期,这些股份的总价值约为4530万美元。如果ACIC没有在2023年8月14日之前完成业务合并或其他初始业务合并,因此ACIC被要求清算,这些股份将一文不值,因为Founder Shares无权参与信托账户的任何赎回或清算。根据保荐人为创始人股份支付的实际购买价格约为每股0.006美元,与首次公开发行中每单位10.00美元的购买价格相比,即使合并后公司的股价在收盘后低于首次公开发行中最初为ACIC单位支付的价格,并且ACIC公众股东在收盘后经历负回报率,保荐人仍可获得正回报率; |
| ● | 保荐人以每份私人认股权证1.00美元购买的8,200,000份私人认股权证,如果不能完成业务合并,这些认股权证将一文不值(尽管私人认股权证的某些权利与公开认股权证持有人的权利不同,假设私人认股权证的每份认股权证价值与公开认股权证2023年5月9日在OTCM上的0.04美元收盘价相同,保荐人持有的8,200,000份私人认股权证的总价值估计约为328,000美元); |
| ● | 如果ACIC无法完成其初始业务合并,ACIC的内部人士已放弃在ACIC清算时赎回其创始人股份及其持有的任何其他普通股的权利,或从信托账户获得有关创始人股份的分配; |
| ● | 除非ACIC完成初始业务合并,否则其董事和高级管理人员将不会获得补偿,以补偿他们因业务合并而产生的任何自付费用(只要这些费用超过未存入信托账户的可用收益的数额)。截至[·],2023年,ACIC的任何董事或高级职员都没有发生任何他们预期在交易结束时得到补偿的费用; |
21
| ● | 继续向ACIC现任董事和高级职员提供赔偿,并在业务合并后继续提供董事和高级职员责任保险; |
| ● | 内部人可能被激励完成企业合并,或与不那么有利的公司进行替代的初始企业合并,或以对股东不那么有利的条件进行清算,而不是清算,在这种情况下,内部人将损失其全部投资。因此,内部人士在确定GIO是否是与之进行业务合并的适当企业和/或在评估业务合并的条款方面可能存在利益冲突;以及 |
| ● | 预计在业务合并完成后,ACIC首席执行官、总裁兼董事长Joel Shulman博士将被选举为合并后公司的董事。因此,在未来,该董事将获得合并后的公司董事会决定支付给其董事的任何现金费用、股票期权或股票奖励。 |
除了ACIC的内部人士在企业合并中的利益外,ACIC的股东还应该意识到,Cantor可能拥有与ACIC股东的利益不同或不同的财务利益,包括Cantor及其指定人员拥有75万份私人认股权证,这些认股权证由Cantor以每份私人认股权证1.00美元的价格购买,如果企业合并不能完成,这些认股权证将一文不值。虽然私人认股权证的某些权利不同于公开认股权证持有人的权利,但Cantor或其指定人员持有的750,000份私人认股权证的总价值估计约为[·]美元,假设私人认股权证的每份认股权证价值与公开认股权证在2023年[·]日在OTCM上的收盘价[·]美元相同;
还请参阅“企业合并中的某些其他权益”、“某些关系和关联人交易”和“证券的实益所有权”部分,以获取有关ACIC的内部人士和GIO的董事和高级管理人员在企业合并中的利益和关系的更多信息。
问:为什么ACIC会提出业务合并?
答:ACIC的成立是为了与一个或多个企业进行合并、股份交换、资产收购、股票购买、资本重组、重组或其他类似的业务合并。自ACIC成立以来,ACIC董事会一直在努力物色合适的候选人,以促成此类交易。在审查GIO时,ACIC理事会审议了与业务合并有关的各种积极和消极因素。经过认真考虑,ACIC董事会认为,企业合并提供了一个有吸引力的企业合并机会,符合ACIC及其股东的最佳利益。ACIC董事会认为,根据其审查和考虑,与GIO的业务合并提供了增加股东价值的机会。但是,不能保证业务合并的预期效益能够实现。企业合并协议和现行章程要求ACIC股东批准企业合并。
问:业务合并将会发生什么?
答: |
根据业务合并协议,在符合协议规定的条款和条件下,卖方将向ACIC出售,而ACIC将向卖方购买卖方拥有的GIO的所有普通股(“购买的股份”),以换取新发行的ACIC A类普通股。任何GIO期权、认股权证和其他未在收盘前转换为普通股的可转换证券将在收盘时终止。 |
问:对于ACIC收购GIO,卖方将获得何种形式的对价以及多少对价?
答: |
根据业务合并协议的条款,向卖方交付的对价将是ACIC A类普通股的一些新发行股份,总价值为2.50亿美元乘以百分比,等于(i)购买的股份总数除以(ii)GIO已发行和未发行的股本股份总数加上GIO库存股本股份的数量。GIO在交割后立即以库存形式持有的任何股本将由GIO注销。卖方目前是企业合并协议的一方,合计持有GIO已发行和流通普通股的98.703%;其他GIO股东可在交易结束前通过在登记声明生效后签署合并协议成为企业合并协议的一方。 |
除在收盘时可交付的交易所对价外,在收盘后,盈利卖方可能有权获得额外的ACIC A类普通股股份,其数量不超过54,000,000股乘以所购买的
22
在从生效时间开始到截止日期五周年结束的期间(“盈利期”)满足某些指标的情况下的份额百分比。具体来说:
| ● | 如果在盈利期内,ACIC A类普通股在主要证券交易所或证券市场的成交量加权平均交易价格在连续三十个交易日内的任何二十个交易日内(以下简称“交易价格")大于或等于12.50美元,盈利卖方将有权获得总计15000000股盈利股票乘以所购股票百分比; |
| ● | 如果在盈利期内,交易价格高于或等于15.00美元,则盈利期卖方将有权获得总计18,000,000股额外盈利期股票乘以所购股票百分比;以及 |
| ● | 如果在盈利期内的任何时间和当日,交易价格大于或等于17.50美元,则盈利卖方将有权获得总计21,000,000股额外盈利股票乘以所购股票百分比。 |
如果在盈利期内,合并后公司的控制权发生变更,据此合并后公司或其股东有权收取对价,该对价意味着A类普通股的每股价值等于或超过一个或多个触发事件所依据的交易价格,那么,在此控制权变更完成之前,(i)在相关触发事件以前未曾发生的范围内,此类相关触发事件应被视为已经发生,并且(ii)每个盈余卖方应有权根据被视为发生的适用触发事件获得其所发行的适用盈余股票数量的按比例份额。
问:ACIC董事会在决定是否继续进行业务合并时,是否获得了第三方的估价或公平意见?
答: |
是的,ACIC董事会从EverEdge获得了公平意见。有关EverEdge向ACIC董事会发布的意见的描述,请参阅“业务合并建议—— ACIC财务顾问的意见”。 |
问:在业务合并完成后,现任ACIC公众股东、内部人士和GIO卖方将立即持有合并后公司的哪些股权?
答: |
选择不赎回其公众股份的ACIC股东将因业务合并而遭受重大稀释。ACIC公众股东目前拥有ACIC普通股约25.8%的流通股。如果没有ACIC股东在企业合并完成前赎回他们的普通股股份,并且没有行使未行使的公开认股权证或私募认股权证,考虑到“股份计算和所有权百分比”中列出的其他假设。ACIC公众股东预计将在交割后立即拥有合并后公司已发行股份总数的约5.1%,前提是本委托书/招股说明书的备考财务报表部分纳入BCA最大赎回情景的其他假设在交割时也适用,以及在BCA最大赎回情景下合并后公司已发行股份总数的约4.1%。合并后,将有多达8,625,000份公开认股权证和8,200,000份私募认股权证尚未偿付。赎回普通股的ACIC股东可以继续持有他们在赎回前拥有的任何公开认股权证,行使公开认股权证将导致非赎回ACIC股东的额外稀释。如果在收盘后满足适用的盈利条款,可能发行盈利股票,也会对非赎回的ACIC股东造成额外的稀释。此外,在交易结束时,经ACIC股东批准,ACIC预计将采用激励计划,根据该计划,在交易结束后发放的赠款将进一步稀释合并后公司的股东。 |
公众股东作为一个整体将拥有的合并后公司普通股流通股总数的百分比将根据企业合并前赎回的公众股数量而变化。下表说明了合并后公司不同的实益所有权水平,以及非赎回公共股东可能的稀释来源和程度,假设公共股东没有赎回,公共股东赎回25%
23
股东,50%由公众股东赎回,75%由公众股东赎回和BCA最大赎回假设关于公众股东赎回:
| ● | 假设没有赎回情形:本演示文稿假定没有公众股东对其公众股份行使赎回权。 |
| ● | 假设25%的赎回情形:本演示文稿假定持有约5.44%公众股份的公众股东对其公众股份行使赎回权,即在BCA最大赎回情形下假定赎回的公众股份的约25%。这一设想假设赎回81,720股公众股票,赎回付款总额约为855,772美元,加上信托账户应计利息的按比例部分(以前未发放给ACIC缴税)。 |
| ● | 假设50%赎回情形:本演示文稿假定持有约10.88%公众股份的公众股东对其公众股份行使赎回权,即在BCA最大赎回情形下假定赎回的公众股份的约50%。这一设想假设10.88%的公众股份被赎回,赎回付款总额约为1711544美元,加上信托账户应计利息的按比例部分(以前没有交给ACIC缴税)。 |
| ● | 假设75%的赎回情形:本演示文稿假定持有约16.32%公众股份的公众股东对其公众股份行使赎回权,即在BCA最大赎回情形下假定赎回的公众股份的约75%。这一设想假设245161股公众股票被赎回,赎回付款总额约为2567316美元,加上信托账户应计利息的按比例部分(以前没有交给ACIC缴税)。 |
| ● | 假设BCA最大赎回:这一列报方式,如题为“未经审计的合并财务报表附注”一节进一步说明BCA最大赎回方案")假设(i)326881股公众股被赎回,赎回付款总额为340万美元,假设根据截至2023年4月30日信托账户的资金计算的每股赎回价格为10.47美元,以及(ii)如果ACIC在收盘时没有现金或现金等价物,拟议的业务合并将不会完成,包括信托账户中的剩余资金(在完成和支付赎回后)和任何交易融资的收益,至少相当于在交易结束时支付ACIC和GIO的估计交易费用和负债所需的金额(“费用条件”,如下文进一步描述)。由于ACIC的所有Insiders在ACIC IPO时都放弃了赎回权,本演示文稿中只反映了公众股东的赎回。这一设想方案包括“无赎回”设想方案中所载的所有调整,并提出额外调整,以反映BCA最大赎回设想方案的影响,同时考虑到费用条件。“BCA最大赎回情形”(i)假设NTA提案在特别会议上获得ACIC股东的批准,并且(ii)代表在满足费用条件的情况下可赎回的最大公众股份数量;但是,前提是根据业务合并协议的条款,费用条件不是完成交易的合同条件,并且业务合并可以在不满足费用条件的情况下按照合同交易条款完成。如果企业合并在费用条件未得到满足的情况下完成(或者,如果估计的交易费用或任何交易融资的收益(如果有的话)导致截至交割日的费用条件与本BCA最大赎回情景演示文稿中包含的假设不同),最多可赎回“BCA最大赎回情景”中所反映的1175322股公众股票。 |
稀释的潜在来源:(1)
|
无 |
|
% |
|
25% |
|
% |
|
50% |
|
% |
|
75% |
|
% |
|
BCA |
|
% |
|
|
ACIC公众股东 |
1,502,203 |
5.1 |
% |
1,420,483 |
4.8 |
% |
1,338,763 |
4.6 |
% |
1,257,042 |
4.3 |
% |
1,175,322 |
4.0 |
% |
||||||
ACIC Founder Shares |
4,312,500 |
14.6 |
% |
4,312,500 |
14.7 |
% |
4,312,500 |
14.8 |
% |
4,312,500 |
14.8 |
% |
4,312,500 |
14.8 |
% |
||||||
GIO股东 |
23,568,155 |
80.3 |
% |
23,568,155 |
80.5 |
% |
23,568,155 |
80.6 |
% |
23,568,155 |
80.9 |
% |
23,568,155 |
81.2 |
% |
||||||
合计 |
29,382,858 |
100.0 |
% |
29,301,137 |
100.0 |
% |
29,219,417 |
100.0 |
% |
29,137,697 |
100.0 |
% |
29,055,977 |
100.0 |
% |
24
稀释的潜在来源:(1)
|
无 |
|
25% |
|
50% |
|
75% |
|
BCA |
|
公开认股权证 |
8,200,000 |
8,200,000 |
8,200,000 |
8,200,000 |
8,200,000 |
|||||
私人认股权证 |
8,625,000 |
8,625,000 |
8,625,000 |
8,625,000 |
8,625,000 |
|||||
已发行完全稀释股份总数 |
46,207,858 |
46,126,137 |
46,044,417 |
45,962,697 |
45,880,977 |
就首次公开发行向Cantor支付的现金费用共计3000000美元,不会根据收盘时公众股东赎回的次数进行调整。
下表说明了按百分比计算的公众股份在以下每个赎回水平的有效承销商现金费用。
(以千为单位,股份数额除外) |
|
无 |
|
25% |
|
50% |
|
75% |
|
BCA |
|
|||||
未赎回的公众股份 |
1,502,203 |
1,420,483 |
1,338,763 |
1,257,042 |
1,175,322 |
|||||||||||
信托收益给GIO |
$ |
15,731,024 |
$ |
14,875,252 |
$ |
14,019,480 |
$ |
13,163,708 |
$ |
12,307,940 |
||||||
承销商现金费用 |
$ |
9,075,000 |
$ |
9,075,000 |
$ |
9,075,000 |
$ |
9,075,000 |
$ |
9,075,000 |
||||||
有效承保人现金费用(%) |
57.7 |
% |
61.0 |
% |
64.7 |
% |
68.9 |
% |
73.7 |
% |
||||||
问:业务合并完成后,存入信托账户的资金将如何处理?
答: |
在企业合并完成后,信托账户中的资金将用于支付行使赎回权的公众股东,并在支付赎回款项后支付ACIC和GIO与企业合并有关的交易费用,以及ACIC的其他费用和负债(包括应付给Cantor的递延IPO费用)。截至2023年[ ● ]日,信托账户中的投资和现金约为[ ● ]百万美元。如果ACIC不能在2023年8月14日之前完成业务合并,则这些资金将在完成业务合并或赎回公众股份(以较早者为准)之前发放(但信托账户所持金额所赚取的利息可在支付ACIC税款所需时提前发放)。如果业务合并完成,并且在偿付与赎回有关的付款以及支付上述费用和负债后,任何剩余资金将可供合并后的公司用于一般营运资金用途。 |
问:我有赎回权吗?
答: |
如果你是公众股东,你有权就本委托书/招股说明书中所述的拟议业务合并和提议,要求ACIC按比例赎回这些股份,以换取信托账户中所持现金的一部分,该部分是在业务合并完成前两个工作日计算的。我们有时将要求赎回公众股份的权利称为“赎回权”。 |
尽管有上述规定,公众股东,连同其任何附属公司或与该股东一致行动的任何其他人,或作为一个“集团”(定义见《交易法》第13(d)(3)节),将被限制就15%或以上的公众股份寻求赎回权。因此,公众股东持有的超过15%的所有公众股份,连同该持有人的任何关联公司或与该持有人一致行动或作为一个“集团”的任何其他人,将不会被转换。
根据现行章程,如果ACIC在企业合并完成之前或完成时不拥有至少5000,001美元的有形净资产,考虑到公众股东适当要求赎回的所有公众股份的现金赎回,ACIC将不赎回任何公众股份。
25
问:为什么ACIC会提出NTA提案?
答: |
核准NTA提案可允许公众股东赎回,从而有助于完成企业合并,即使这种赎回导致ACIC的有形资产净值低于5000,001美元。净资产测试限制的目的最初是为了确保根据《交易法》第3a51-1条,ACIC A类普通股不被视为“细价股”。由于根据《交易法》第3a51-1条的其他适用条款,ACIC的A类普通股不会被视为“细价股”,ACIC提交NTA提案是为了让双方能够完成企业合并,即使IWAC在收盘时的有形资产净值为5,000,000美元或更少。 |
问:如果ACIC的大量公众股东投票支持企业合并提案并行使他们的赎回权,会发生什么?
答: |
ACIC的公众股东可以投票赞成企业合并,但仍可行使其赎回权,前提是,除非NTA提案获得批准和实施,否则ACIC将不会赎回任何公众股份,前提是在考虑到公众股东适当要求赎回的所有公众股份的现金赎回后,ACIC在企业合并完成之前或完成后不会拥有至少5,000,001美元的有形净资产。即使信托账户的可用资金和公共股东人数因公共股东赎回而大幅减少,企业合并也可能完成。 |
问:完成业务合并必须满足哪些条件?
答: |
除了核准所需提案外,《企业合并协议》中还有一些成交条件。有关交割前必须满足或放弃的条件的摘要,请参见标题为“提案1:企业合并提案——企业合并协议——企业合并交割的条件”的部分。 |
问:如果业务合并没有完成,会发生什么?
答: |
如果ACIC无法在2023年8月14日之前完成业务合并或另一项初始业务合并,ACIC将停止所有业务,但清盘和赎回其公众股份以及清算信托账户的目的除外,在这种情况下,ACIC的公众股东只能在适用的赎回日期收到信托账户中的金额(减去之前为支付任何税款而在信托账户中持有的金额所赚取的任何利息),该金额将仅为每股约[·]美元,根据信托账户截至2023年[·]的持有量,ACIC的认股权证将到期,没有任何价值。 |
问:你预计业务合并什么时候完成?
答: |
目前预计,在定于2023年[·]举行的特别会议之后,业务合并将在切实可行的范围内尽快完成;但是,(i)如果ACIC的股东在特别会议上通过了休会提案,并且ACIC董事会决定将特别会议推迟到一个或多个日期,则可以休会;以及(ii)在满足或放弃业务合并协议中规定的所有条件之前,不会结束会议。有关完成业务合并的条件的说明,见“建议1:业务合并建议——业务合并协议——完成业务合并的条件”。 |
问:股东们被要求对哪些提案进行投票?
答:
| ● | 提案1:业务合并提案 |
| ● | 提案2:NTA提案 |
| ● | 提案3:《宪章》提案 |
| ● | 提议4-9:组织文件提议 |
26
| ● | 建议10:奖励计划建议 |
| ● | 提案11:董事选举提案 |
| ● | 提案12:休会提案 |
如果ACIC的公众股东不批准每一项必要的提案,那么企业合并将不会完成。
根据适用的SEC指南的要求,股东有机会就重要的公司治理条款发表意见,ACIC要求其股东在不具约束力的咨询基础上对组织文件提案进行投票,以批准拟议章程中包含的对股东权利有重大影响的某些治理条款,并将结合拟议章程予以通过。见“提案4-9:组织文件提案”。这些单独的投票不是特拉华州法律要求的,但根据美国证交会的指导,ACIC必须将这些规定单独提交给股东批准。然而,股东对这些提案的投票是咨询投票,对ACIC或ACIC董事会没有约束力。此外,业务合并不以单独核准组织文件提案为条件。
经审慎考虑后,ACIC董事会已批准《业务合并协议》及其拟进行的交易,并确定《业务合并提案》、《NTA提案》、《章程提案》、《组织文件提案》、《激励计划提案》、《董事选举提案》和《休会提案》均符合ACIC及其股东的最佳利益,并建议你对每一项提案投“赞成”票或指示投票“赞成”。
股东的投票很重要。请股东在仔细审查本委托书/招股说明书后尽快提交其委托书。
问:ACIC董事会考虑了与业务合并有关的哪些重大负面因素?
答: |
行政协调会理事会在评价业务合并时考虑的重大负面因素包括: |
| ● | 每个业务线都具有前瞻性,GIO为其计划的业务线制定的战略可能由于各种已知或未知的原因而部分或全部无法按预期实现,GIO可能无法在近期或根本无法获得收入或实现盈利; |
| ● | GIO业务的前瞻性和能力的发展性使得GIO的潜在未来价值难以评估; |
| ● | GIO执行其商业计划的能力取决于GIO能否获得资本和其他资源,而GIO可能根本无法以优惠条件获得这些资源; |
| ● | GIO可能无法按照GIO管理层预期的方式或时间表开发其计划的产品和服务,如果开发出来,GIO计划提供的产品和服务可能不会被市场参与者或客户接受,或者可能无法与其他公司的类似产品竞争;以及 |
| ● | 迄今为止,GIO在其计划的业务线开发中可能依赖的部分或全部知识和商业秘密是由GIO的首席科学官Srivastava博士和由Srivastava博士指导的其他人开发的,这些人目前不受GIO雇用或与GIO有关联,GIO为实现其目标所依赖的一些知识产权是全球干细胞治疗和研究公司(“GIOSTAR”)的权利,该公司已授权GIO使用这些权利,并将在完成业务合并之前,与GIO订立(i)有关使用该等权利的若干额外协议,以及(ii)为GIO提供其未来活性化妆品业务所需材料的协议。如下文所述,GIOSTAR是GIO的主要股东,由Srivastava博士和Patel先生拥有和控制;GIO预计将依赖这些权利,至少在业务合并后的最初阶段,并依赖Patel先生在其增长和发展计划方面的专业知识。如果Srivastava博士或Patel先生由于任何原因不再是GIO的一部分或减少参与GIO,或由于任何原因GIOSTAR、Srivastava博士和任何其他相关人员改变、放弃或不完全遵守其承诺 |
27
| 向GIO或任何上述人员(包括GIOSTAR、Patel先生、Srivastava博士和其他相关人员)提供、转让或以其他方式提供所有相关的知识产权、专有技术和商业秘密,这些人员在GIO之外从事与GIO的活动相竞争的活动,GIO的业务和经营业绩将受到影响,GIO可能没有追索权来弥补由此产生的任何损失,可能无法继续其当前的业务计划或为股东实现价值。 |
这些因素在题为“提案1:企业合并提案—— ACIC董事会的建议和企业合并的原因”一节以及题为“风险因素——与企业合并相关的风险”一节中有更详细的讨论。
问:公开认股权证与私人认股权证有何不同?企业合并后,公开认股权证的持有者面临哪些相关风险?
答: |
私人认股权证在所有重大方面与公开认股权证相同,但私人认股权证不能由合并后的公司赎回,而且可以在无现金的基础上行使,在每种情况下,只要这些认股权证由保荐人或Cantor(如适用)或其允许的受让人持有。如果私人认股权证由非保荐人或Cantor(如适用)或其许可受让人持有,则私人认股权证将可由合并后的公司在所有赎回情形下赎回,并可由持有人在与公开认股权证相同的基础上行使。 |
合并后,合并后的公司可在行使公开认股权证之前,在对持有人不利的时间赎回这些认股权证,从而大大损害这些认股权证的价值。合并后的公司将有能力在可行使的公开认股权证到期之前的任何时间,以每份认股权证0.01美元的价格赎回未偿还的公开认股权证,条件是普通股的收盘价等于或超过每股18.00美元(可根据拆分、股息、资本重组和其他类似事件进行调整),在向认股权证持有人发出赎回通知之日前的第三个营业日结束的30个交易日内的任何20个交易日内。合并后的公司将不会按上述方式赎回认股权证,除非根据《证券法》提供的关于在行使认股权证时可发行的普通股股份的登记声明生效,并且在整个30天的赎回期内可获得与这些普通股股份有关的现行招股说明书,除非认股权证可以在无现金的基础上行使,并且根据《证券法》此种无现金的行使免于登记。如果合并后的公司可以赎回公开认股权证,如果合并后的公司选择要求在无现金的基础上行使公开认股权证,合并后的公司可以按上述方式赎回认股权证,即使它不能根据所有适用的州证券法对公开认股权证的基础股票进行登记或使其符合出售条件。赎回尚未赎回的公开认股权证可能会迫使你(i)行使你的公开认股权证,并在可能对你不利的时候支付行使价格,(ii)在你可能希望持有公开认股权证时,以当时的市场价格出售你的公开认股权证,或(iii)接受名义赎回价格,而在要求赎回尚未赎回的公开认股权证时,该价格可能大大低于公开认股权证的市场价值。
如果合并后的公司决定赎回公开认股权证,可赎回认股权证的持有人将被通知按照认股权证协议的规定赎回。具体而言,如果本公司选择按上述方式赎回所有可赎回认股权证,合并后的公司将确定赎回日期(“认股权证赎回日期”)。赎回通知书将由合并后的公司在认股权证赎回日期前不少于30天,以预付邮资的第一类邮件,寄往将予赎回的认股权证的登记持有人在登记簿册上的最后地址。以担保协议规定的方式邮寄的任何通知,将被最终推定为已妥为发出,无论登记持有人是否收到此种通知。此外,可赎回认股权证的实益拥有人将通过合并公司向DTC发出赎回通知而获得赎回通知。截至2023年[·],普通股股票的收盘价为[·]美元,从未超过18.00美元的门槛,这将触发在收盘后赎回公开认股权证的权利。
问:我如何行使我的赎回权?
答: |
根据现行章程,如果企业合并完成,公众股东可要求ACIC赎回其全部或部分公众股份,但须遵守某些限制,以换取相当于信托账户可用资金按比例部分的现金;但前提是,如果ACIC在企业合并完成之前或完成后没有至少5,000,001美元的有形资产净值,考虑到公众股东适当要求赎回的所有公众股份的现金赎回情况,ACIC将不会赎回任何公众股份。截至2023年[·], |
28
根据截至该日信托账户的资金约为[·]百万美元,信托账户中可供赎回的资金的按比例部分约为每股[·]美元。
只有在以下情况下,你方有权获得赎回任何公众股份的现金:
| a) | 持有公众股份或透过ACIC单位持有公众股份,而你在行使有关公众股份的赎回权前,选择将你的ACIC单位分离为基础公众股份及认股权证;及 |
| b) | 美国东部时间下午5时前,在[·]、2023年(特别会议投票前两个工作日)(或ACIC自行决定批准的较后日期)(或ACIC自行决定批准的较后日期),(i)向转让代理提交书面请求,要求ACIC以现金赎回您的公众股份,以及(ii)通过DTC以实物或电子方式将您的股票(如有)和其他赎回表格交付给转让代理。 |
ACIC单位的持有人在行使有关公众股份的赎回权之前,必须选择将基础公众股份和认股权证分开。持有人可以指示其银行、经纪人或其他代名人这样做,或者,如果持有人持有以自己的名义注册的ACIC单位,持有人必须直接与转让代理人联系并指示其这样做
公众股东可以选择赎回其全部或部分公众股份,无论他们是否投票赞成或反对企业合并提案。
任何赎回要求一经提出,可随时撤回,直至要求赎回的截止日期,其后经ACIC同意,直至企业合并完成,或ACIC董事会确定的其他日期。如果您将您的股票交付给转让代理赎回,并在规定的时间范围内决定不行使您的赎回权,您可以要求转让代理返还股票(实物或电子)。您可以通过本节末尾所列的电话号码或地址与传输代理联系,提出此类请求。
ACIC首席执行官必须在特别会议就业务合并进行表决前两个工作日收到任何更正或更改的赎回权利书面要求。除非持有人的股票(如有的话)及其他赎回表格已于特别会议表决前至少两个营业日(以实物或电子方式)交付转让代理人,否则赎回要求将不会获履行。
寻求行使赎回权并选择交付实物证书和其他赎回形式的公众股东应分配足够的时间从转让代理获得实物证书和交付时间。根据ACIC的理解,股东一般应至少分配两周时间从转让代理获得实物证书。然而,ACIC对这一过程没有任何控制权,可能需要两周以上的时间。以街道名义持有股份的公众股东必须与其银行、经纪人或其他被提名人协调,以电子方式证明或交付股份。这一招标过程以及通过DWAC系统对股票进行认证或交付的行为都有名义上的成本。转让代理通常会向投标银行、经纪人或其他代名人收取象征性的费用,是否将这笔费用转嫁给赎回股东将取决于银行、经纪人或其他代名人。如果企业合并没有完成,这可能会导致股东返还股份的额外成本。
如果公众股东如上文所述正确要求赎回,并且企业合并完成,ACIC将赎回股份。这些款项将在业务合并完成后立即支付。如果您行使您的赎回权,那么您将把您的ACIC普通股股票换成现金,并且在业务合并后将不再拥有这些股票。
如果你是一个公众股东,行使你的赎回权将不会导致你的任何公开认股权证的行使或损失,这些认股权证将继续未付,并在业务合并完成后可行使。
私人认股权证持有人不享有与企业合并有关的赎回权。
如你拟要求赎回你的公众股份,你须在会议前将你的股票证书(如有的话)及其他赎回表格(实物或电子形式)送交转让代理,正如本代理声明/招股章程所述。如果你对你的职位证明或你的股份交付有疑问,请联系:
29
Continental Stock Transfer & Trust Company
道富一号,30号第楼层
纽约,纽约10004
注意:Mark Zimkind
电子邮件:mzimkind@continentalstock.com
问:我就业务合并建议投票的方式,会否影响我行使赎回权的能力?
答: |
没有。如果你有赎回权,你可以行使你的赎回权,无论你是否投票赞成或反对你的普通股合并建议或任何其他建议,在本代理声明/招股说明书。 |
问:如果我是ACIC单位的持有人,我是否可以就我的ACIC单位行使赎回权?
答: |
没有。未偿付的ACIC单位的持有人必须选择将ACIC单位分离为基础的公开股份和公开认股权证,然后才能对公开股份行使赎回权。如果您在银行、经纪商或其他代名人的账户中持有ACIC单位,您必须通知您的银行、经纪商或其他代名人,您选择将ACIC单位分为基础的公开股票和公开认股权证,或者如果您持有以您自己的名义注册的ACIC单位,您必须直接联系转让代理并指示他们这样做。如果您未能在2023年[·]美国东部时间下午5:00之前将您的公众股份分离并交付给转让代理,您将无法就您的公众股份行使您的赎回权。 |
问:美国联邦所得税对行使赎回权的美国持有人有什么重大影响?
答: |
有关美国联邦所得税对行使赎回权的美国持有人的重大后果的描述,请参见标题为“提案1:企业合并提案——企业合并对ACIC股东的重大美国联邦所得税后果”一节中的描述。 |
问:我是否就建议的业务合并拥有评估权?
答: |
ACIC的股东不享有与DGCL下的业务合并有关的评估权。 |
问:我现在需要做什么?
答: |
ACIC促请你仔细阅读和考虑本代理声明/招股说明书中的信息,包括附件,并考虑业务合并将如何影响你作为ACIC的股东。然后,ACIC股东应尽快按照本代理声明/招股说明书和随附的代理卡上提供的指示进行投票。 |
问:我该如何投票?
答: |
特别会议将于美国东部时间2023年[·]上午[·]通过网络直播举行。可通过以下网址访问特别会议:https://www.cstproxy.com/[·],您将在会上收听现场会议和投票。 |
如果你在记录日期是ACIC普通股的记录持有人,你可以在特别会议上投票或提交特别会议的代理人。你可以填写、签署、注明日期并将随附的代理卡放入预先写好邮资的已付邮资信封中寄回,以提交你的代理。如果你以“街道名称”持有你的股票,这意味着你的股票由银行、经纪人或代名人持有,你应该联系你的银行、经纪人或其他代名人,以确保与你实益拥有的股票相关的投票被正确计算。在这方面,你必须向银行、经纪人或代名人提供关于如何投票表决你的股票的指示,或者,如果你想出席特别会议并投票,你必须向你的银行、经纪人或其他代名人索取代理人。
问:我可以在提交我的代理后更改我的投票吗?
是的。你可以在特别会议最后表决前随时撤销你的代理。如果你是你股票的记录持有人,你可以以下列任何一种方式撤销你的代理:
30
| ● | 您可以提交另一张正确填写的代理卡,日期要晚一些。 |
| ● | 您可以通过电话或在线方式授予后续代理。 |
| ● | 您可以及时向ACIC的首席执行官发送一份书面通知,通知您撤销代理,地址为:175 Federal Street,Suite 875,Boston,Massachusetts 02110。 |
| ● | 你可以出席特别会议并以虚拟方式投票。仅仅参加特别会议而不进行表决,实际上并不会使你的代理人被撤销。 |
通过电话或在线提交的您最新的代理卡或代理卡是被计算在内的那张。
实益拥有人:以银行、经纪或其他代名人名义登记的股份
如果你的股票由你的经纪人、银行或其他代名人持有,你应该遵循他们提供给你的指示。
问:如果我的股票以“街道名称”持有,我的银行、经纪人或其他代名人会自动为我投票吗?
答: |
没有。如果你的股票由银行、经纪人或其他代名人持有,你就会被视为以所谓的“街道名称”为你持有的股票的“实益持有人”。如果是这种情况,本委托书/招股说明书可能已由你的经纪公司、银行或其他代理人或其代理人转交给你。 |
作为实益持有人,你有权指示你的经纪人、银行或其他代名人如何投票表决你的股票。如果你不提供投票指示,经纪人仍然可以就被视为“常规”的事项投票,但不能就“非常规”事项投票。如果经纪人就“常规”事项投票,但不就“非常规”事项投票,这些股票将被视为经纪人就“非常规”提案不投票。因此,如果你通过银行、经纪人或其他代名人持有股票,请务必指示你的银行、经纪人或其他代名人如何投票,以确保你对每一项提案的投票都被计算在内。
除休会提案外,每一项提案都属于非例行提案,因此,行政协调会预计在行政协调会特别会议上不会有任何中间人对这些提案投反对票。ACIC预计,延期提案将被视为常规事项,这意味着您的经纪人或其他代名人将有权就延期提案对您以街道名义持有的股份进行投票。因此,如果你没有指示你的经纪人或代名人投票表决你的股票,经纪人或其他代名人可以(a)就延期提案投票表决你的股票,或(b)完全不投票表决你的股票。
问:特别会议将在何时何地举行?
答: |
特别会议将于2023年东部时间[·]上午[·]通过网络直播举行,除非特别会议休会。 |
可通过以下网址访问特别会议:https://www.cstproxy.com/[·],在特别会议期间,你可以收听现场会议和投票。
问:我如何登记和参加虚拟特别会议?
答: |
如果你是注册股东,你收到了大陆集团的代理卡。该表单包含有关如何参加虚拟特别会议的说明,包括URL地址以及您的控制号码。你需要你的控制号码才能进入。如果您没有自己的控制号码,请致电917-262-2373与大陆集团联系,或发送电子邮件至proxy@continentalstock.com。 |
您可以预先登记参加东部时间2023年[·]上午[·]开始的虚拟会议。在浏览器中输入URL地址https://www.cstproxy.com/[·],输入控制号、姓名和电子邮件地址。一旦你预先登记,你就可以投票你的股份。在会议开始时,您需要使用您的控制号码重新登录,如果您在会议期间投票,系统还会提示您输入您的控制号码。
31
通过银行、经纪商或其他代名人拥有其投资的实益投资者需要联系大陆集团以获得一个控制号码。如果你计划在特别会议上投票,你将需要有一个来自你的银行、经纪人或其他代名人的法定代理人,或者如果你想加入而不是投票大陆集团将向你发出一个带有所有权证明的客人控制号码。
请在特别会议召开前最多留出72小时处理你的控制号码。
如果您没有互联网功能,您可以在美国和加拿大以外地区拨打1 800-450-7155(免费电话)或+ 1 857-999-9155(适用标准费率),通过只听格式参加特别会议;当出现提示时,请输入密码[·]。这是只听模式,你将不能在会议期间投票或输入问题。
问:谁有权在特别会议上投票?
答: |
ACIC已确定[·],2023年为记录日期。如果你在记录日期营业结束时是公众股东,你有权就特别会议审议的事项投票。但是,公众股东只有在出席特别会议或由代理人代表出席特别会议时才能投票。 |
问:我有多少票?
答: |
在特别会议上,公众股东有权对截至记录日期已记录在案的每一股普通股有一票表决权。截至记录日期收市时,共有5,814,703股普通股尚未发行。 |
问:什么构成法定人数?
答: |
代表有权在特别会议上投票的所有未发行股票的多数表决权的已发行和未发行的ACIC普通股的持有人亲自或由代理人代表,即构成法定人数。在未达到法定人数时,会议主席有权按照附例的规定休会。 |
截至特别会议的记录日期,达到法定人数需要2,907,352股普通股。
问:在特别会议上批准每项提案需要多少票?
答: |
在特别会议上,每项提案均需获得以下表决: |
| ● | 业务合并提案:企业合并提案要求获得在特别会议上投票的ACIC普通股多数股东的赞成票。 |
| ● | NTA提案:NTA提案要求持有作为单一类别共同投票的ACIC普通股的多数股东投赞成票。 |
| ● | 宪章提案:《章程》提案必须获得持有已发行ACIC普通股多数股份的股东(包括持有B类股份多数股份的股东,作为单独类别投票)的赞成票。 |
| ● | 组织文件提案:组织文件提案,每一项都是不具约束力的咨询投票,必须得到已发行ACIC普通股多数股东的赞成票。 |
| ● | 奖励计划提案:激励计划提案要求获得在特别会议上投票的ACIC普通股多数股东的赞成票。 |
| ● | 董事选举提案:选举被提名的董事需要出席特别会议或由代理人代表出席特别会议的ACIC普通股股东的多数票。“多元化”指的是,获得“赞成”票数最多的个人当选为董事。 |
| ● | 休会提案:暂停提案要求获得在特别会议上投票的ACIC普通股多数股东的赞成票。 |
保荐人拥有有权在特别会议上投票的ACIC普通股约74.2%的已发行股份,根据内幕消息协议的条款,保荐人已同意对所有所拥有的ACIC股份进行投票
32
由其赞成业务合并及其他建议。根据《现行章程》所载的条款和规定,假定特别会议达到法定人数,并且保荐人按照《内幕信息交易协议》的要求在特别会议上投票表决其股份,即使ACIC的部分或全部公众股东不批准企业合并或其他提案,企业合并和其他提案也可以在特别会议上获得批准。
问:ACIC理事会的建议是什么?
答: |
ACIC董事会认为,将在特别会议上提交的企业合并提案和其他提案符合ACIC的最佳利益,并建议ACIC的股东对企业合并提案投“赞成”票,对NTA提案投“赞成”票,对章程提案投“赞成”票,对单独的组织文件提案投“赞成”票,对激励计划提案投“赞成”票,对董事选举提案投“赞成”票,如果在特别会议上提交,对休会提案投“赞成”票。 |
ACIC董事和高级管理人员的财务和个人利益的存在可能导致利益冲突,包括在决定建议股东投票支持提案时,符合公司及其股东最佳利益的事项与符合董事个人利益的事项之间的冲突。这些利益冲突包括,如果ACIC不能在2023年8月14日之前完成初始业务合并,ACIC可能会被迫清算,保荐人拥有的4312500股创始人股票和8200000份私人认股权证将一文不值。有关更多信息,请参见标题为“提案1:企业合并提案—— ACIC保荐人、董事和高级管理人员及其他人员在企业合并中的权益”和“证券实益所有权”的章节。
问:保荐人打算如何投票表决其股份?
答: |
拥有ACIC已发行和流通普通股74.2%股份的保荐人,此前已同意将其所有普通股投票支持提交给他们审批的企业合并,包括企业合并。此外,内部人士及其关联公司已同意对他们拥有的任何普通股进行投票,以支持企业合并。 |
问:ACIC的内部人士、GIO或他们各自的关联公司可以在特别会议之前购买公众股份或认股权证吗?
答: |
在特别会议之前的任何时间,在他们不知道有关ACIC或ACIC证券的任何重大非公开信息的时期内,ACIC的内部人士、GIO或他们各自的关联公司可以从投资者那里购买公开股票或公开认股权证,或者他们可以与这些投资者和其他人进行交易,为他们提供激励,以购买普通股或投票支持企业合并提案,或撤回任何赎回请求。在这种交易中,购买普通股的价格不会超过赎回价格。此外,上述人员将放弃对其在此类交易中获得的普通股的任何赎回权。 |
这种股份购买和其他交易的目的是增加完成业务合并的条件得到满足的可能性。这可能会导致我们的业务合并的完成,而这本来是不可能的。尽管截至本代理声明/招股说明书发布之日,任何此类激励措施的确切性质尚未确定,但它们可能包括但不限于保护此类投资者或持有人免受其股票价值潜在损失的安排,包括授予看跌期权。
订立任何此类奖励安排都可能对普通股产生抑制作用。例如,由于这些安排,投资者或持有者可能有能力以低于市场的价格有效购买股票,因此可能更有可能在特别会议之前或之后立即出售其所拥有的股票。
截至本代理声明/招股说明书之日,尚未进行过此类讨论,也未与任何此类投资者或持有人达成任何此类协议。如果订立此类安排或协议,ACIC将在特别会议之前提交一份8-K表格的当前报告,以披露上述任何人订立的任何安排或进行的重大采购。任何此类报告将包括(i)购买的普通股数量和购买价格;(ii)购买的目的;(iii)此类购买对企业合并交易获得批准的可能性的影响;(iv)如果不是在公开市场购买,则出售股票的证券持有人的身份或特征或卖方的性质;以及(v)ACIC收到赎回请求的普通股股份的数量。
33
问:如果我在特别会议之前卖掉股票会怎样?
答: |
特别会议的记录日期早于特别会议的日期,也早于预期的闭幕日期。如果你在记录日期之后,但在特别会议之前转让你的股份,除非你向受让人授予代理权,否则你将保留在特别会议上就这些股份投票的权利,但受让人(而不是你)将有能力赎回这些股份(如果时间允许的话)。 |
问:我可以在邮寄我的签名代理卡后更改我的投票吗?
答: |
是的。股东可按下列地址向ACIC首席执行官寄送一张日期较晚、经签署的代理卡,以便ACIC首席执行官在特别会议(定于2023年[·]举行)投票前收到该卡,或亲自出席特别会议并投票。股东还可以通过向ACIC的首席执行官发送撤销通知来撤销其代理,首席执行官必须在特别会议投票之前收到通知。然而,如果你的股票是由你的银行、经纪人或其他代名人以“街道名称”持有的,你必须联系你的银行、经纪人或其他代名人来改变你的投票。 |
问:如果我未能就特别会议采取任何行动会怎样?
答: |
如果你没有就特别会议采取任何行动,而企业合并得到ACIC股东的批准并完成,你将继续是ACIC的股东或权证持有人。如果你未能就特别会议采取任何行动,而合并业务未获批准,你将继续是ACIC的股东或认股权证持有人。然而,如果你未能就特别会议采取任何行动,你仍可选择赎回与业务合并有关的公众股份,但你须遵从本代理声明/招股章程所载的适用指示。 |
问:我该如何处理我的股票、权证或单位证明?
答: |
根据现行章程,如果企业合并完成,公众股东可要求ACIC将该公众股东的全部或部分公众股份赎回为现金。只有在以下情况下,你方有权获得赎回任何公众股份的现金: |
| (a) | 持有公众股份或透过ACIC单位持有公众股份,而你在行使有关公众股份的赎回权前,选择将你的ACIC单位分离为基础公众股份及认股权证;及 |
| (b) | 美国东部时间下午5时前,在[·]、2023年(特别会议投票前两个工作日)(或ACIC自行决定批准的较后日期),(i)向转让代理提交书面请求,要求ACIC以现金赎回您的公众股份,以及(ii)通过DTC以实物或电子方式将您的股票证书(如有)和其他赎回表格交付给转让代理。 |
如上文所述,ACIC单位的持有人在行使有关公众股份的赎回权之前,必须选择将基础公众股份和公开认股权证分开。持有人可以指示其银行、经纪人或其他代名人这样做,或者,如果持有人持有以自己的名义注册的ACIC单位,持有人必须直接与转让代理联系并指示其这样做。即使公众股东投票支持企业合并提案,他们也可以选择赎回该公众股东的全部或部分公众股份。如果企业合并未完成,公众股份将不会被赎回为现金。如果公众股东正确行使其赎回其公众股份的权利,并及时将其股票(如果有的话)和其他赎回表格交付给转让代理,ACIC将以每股价格赎回每股公众股份,以现金支付,该价格等于在业务合并完成前两个工作日计算的存入信托账户的总金额,包括资金所赚取的利息(扣除所需的税款)除以当时已发行的公众股份数量,再除以当时已发行的公众股份数量。
如果公众股东行使其赎回权,那么它将用其赎回的公众股份换取现金,并且将不再拥有这些股份。任何赎回要求一经提出,可随时撤回,直至要求赎回的截止日期,其后经ACIC同意,直至企业合并完成,或ACIC董事会确定的其他日期。持有人可通过联系转让代理提出此种请求,地址或电子邮件地址列于本代理声明/说明书中。只有在截止日期之前提出的情况下,ACIC才会被要求履行这一要求。
34
要求赎回。请参阅“股东特别会议——赎回权”,详细说明如果您希望将您的公众股份赎回为现金,应遵循的程序。
权证持有人不应提交与其权证有关的任何证书。公众股东如不选择按信托账户的比例赎回其公众股份,则不应提交与其公众股份有关的证书。
在企业合并生效后,普通股和认股权证的持有人将获得合并公司普通股的股份,而认股权证将获得合并公司普通股的股份,而无需采取任何行动,因此,这些持有人不应提交与其普通股或认股权证有关的证书(如果有的话)。合并后,ACIC的证券将不会交易。
问:如果收到一套以上的投票材料,该怎么办?
答: |
股东可以收到一套以上的投票材料,包括本委托书/招股说明书的多份副本和多张代理卡或投票指示卡。例如,如果您在一个以上的经纪账户中持有股票,您将收到一个单独的投票指示卡,用于您持有股票的每个经纪账户。如果你是一个记录持有人,而你的股票以一个以上的名字登记,你将收到一个以上的代理卡。请填写、签名、注明日期并交还您收到的每一张代理卡和投票指示卡,以便对您的所有普通股股份进行投票。 |
问:谁能帮忙回答我的问题?
答: |
如果您对业务合并有疑问,或者您需要代理声明/招股说明书或随附的代理卡的其他副本,您应该联系: |
[·]
您还可以按照“在哪里可以找到更多信息”一节中的说明,从提交给SEC的文件中获得有关ACIC的更多信息。如果你是公众股东,你打算赎回你的股份,你需要在东部时间2023年[·]下午5:00(特别会议投票前两个工作日)(或ACIC自行决定批准的较晚日期)之前,将你的股票证书(如果有)和其他赎回表格(实物或电子形式)送达以下地址的转让代理。如对你的职位证明或交付你的股票(如有的话)及其他赎回表格有疑问,请联络:
马克·齐姆金德
Continental Stock Transfer & Trust Company
道富广场一号,30号第楼层
纽约,纽约10004
电子邮件:mzimkind@continentalstock.com
35
代理声明摘要/前景
本摘要重点介绍了本代理声明/招股说明书中的选定信息,并不包含对您很重要的所有信息。为更好地理解将提交特别会议表决的提案,无论你是否计划出席该会议,包括企业合并提案,你应仔细阅读整份文件,包括作为本代理声明/招股说明书附件A所附的《企业合并协议》。企业合并协议是管理企业合并以及与之相关的其他交易的法律文件。业务合并协议也在本代理声明/招股说明书中题为“业务合并协议”的一节中作了详细说明。本委托书/招股说明书还包括涉及风险和不确定性的前瞻性陈述。见“关于前瞻性陈述的注意事项”。
企业合并的缔约方
ACIC
ACIC是一家特拉华州空白支票公司,于2020年12月28日成立,成立的目的是为了达成合并、股份交换、资产收购、股票购买、资本重组、重组或其他类似的业务合并。
ACIC股票、普通股和认股权证分别在场外交易市场交易,交易代码分别为“APNCU”、“APNC”和“APNCW”。ACIC Units于2021年11月9日在纽约证券交易所开始公开交易,ACIC的普通股和认股权证于2021年12月30日在纽约证券交易所分别开始公开交易。2023年1月31日,ACIC收到纽约证交所员工的书面通知,称其不符合《纽约证交所上市公司手册》第802.01B节的规定,该节要求上市公司在连续30个交易日内保持其公开持有的股票的平均全球总市值至少为40,000,000美元。因此,这些公开发行的证券从纽约证券交易所退市。退市后,ACIC股票、普通股和认股权证开始在OTCM公开交易。ACIC单位,每个单位由一股普通股和半份认股权证(每份整份认股权证赋予其持有人购买一股普通股的权利)组成,在业务合并完成后将自动分离为其组成部分证券,因此,将不再作为单独的证券存在。ACIC单位、普通股和认股权证将不会在收盘后上市。
ACIC的主要行政办公室位于175 Federal Street,Suite 875,Boston,Massachusetts 02110,电话号码是(617)279-0045。
GIO
GIO是一家处于发展阶段的生命科学公司,计划在全球开发和分销精选的基于干细胞的产品和服务。由GIO官员控制的实体,也是GIO的最大股东全球干细胞治疗与研究公司(简称“GIOSTAR”),已授予GIO独家许可(受GIOSTAR在下述特定地区保留的某些分割权的限制),可使用GIOSTAR的所有商业秘密、专有技术和其他机密和专有信息,包括发明、协议、工艺、配方、数据、研究成果和专有技术,以开发和商业化四个干细胞相关领域的产品和服务:全球捐赠红细胞、抗衰老、活性化妆品和COVID治疗。
GIO的战略目前侧重于开发三个主要部门或“业务线”的产品和服务:以干细胞疗法为特色的抗衰老诊所(“Anti-Aging Clinics”);通用供体红细胞(“通用红细胞”)的生产;以及销售成人人类干细胞衍生分子产品,由GIOSTAR(“AHSDM”)提供给化妆品公司,用于其产品或开发、制造和销售包含AHSDM的护肤品(“活性化妆品”)。尽管GIO并不认为它会是其主要关注的领域之一,但GIOSTAR还授予GIO使用其干细胞技术进行COVID相关疗法的独家许可。
GIO的公司总部位于加利福尼亚州圣迭戈,根据2023年3月开始的办公室共享协议,GIO与GIOSTAR在那里共享办公空间。
有关GIO的更多信息,请参阅本文中题为“关于GIO的信息”、“管理层对GIO财务状况和经营成果的讨论与分析”的章节以及GIO的财务报表。
36
采购人代表
Apeiron Capital保荐人有限责任公司将在ACIC的股东(GIO的前权益持有人除外)的生效时间起和生效时间之后以代表身份行事。根据《企业合并协议》,指定买方代表代表公共股东(不包括前GIO证券持有人)。虽然在确定GIO是否适合ACIC的初始业务合并时可能会产生利益冲突,但保荐人在交割后将与合并后公司的公众股东拥有相同的利益,ACIC认为保荐人担任买方代表不存在任何重大风险或冲突。此外,采购人代表的范围和职责的性质有限,主要是行政和部级的。
卖方代表
GIO首席执行官德文·帕特尔将根据业务合并协议的条款和条件,以卖方代表的身份行事。卖方代表的范围和职责的性质是有限的,主要是行政和部级的。
拟在特别会议上提交的提案
提案1:业务合并提案
本节描述了业务合并协议的重要条款,但并不旨在描述业务合并协议的所有条款。以下摘要全文参照附件A所附的《企业合并协议》全文和《附属协议》全文加以限定。我们敦促ACIC的股东和其他利益相关方全面阅读《企业合并协议》,因为它是规范企业合并的主要法律文件。
业务合并协议
根据企业合并协议,在企业合并生效时(“生效时间”),卖方将向ACIC出售,而ACIC将向卖方购买卖方拥有的所有GIO普通股(“购买的GIO股份”),以换取新发行的ACIC A类普通股,每股面值0.0001美元(“ACIC A类普通股”)。任何GIO期权、认股权证和其他可转换证券在业务合并结束前尚未转换为GIO普通股(即“结束”),将于结束时终止。
就业务合并向卖方交付的对价(“对价”)将是ACIC A类普通股的一些新发行股份,总价值为2.50亿美元乘以百分比(“购买股份百分比”),等于(i)购买的GIO股份总数除以(ii)GIO已发行和未发行的股本股份总数加上GIO库存中持有的股本股份数量。GIO在交割后立即以库存形式持有的任何股本股份将由GIO注销。卖方目前是企业合并协议的一方,合计持有GIO已发行和流通普通股的98.703%;其他GIO股东可在交易结束前通过在登记声明生效后签署合并协议成为企业合并协议的一方。
收益
除了在收盘时可交付的对价外,在收盘后,某些卖方(“盈利卖方”)可能有权获得额外的ACIC A类普通股股份,金额不超过54,000,000股乘以所购股份百分比(“盈利股份”),如果在从生效时间开始到截止日期五周年的期间(“盈利期间”)满足某些指标。具体来说:
| a) | 如果在盈利期内,ACIC A类普通股在主要证券交易所或证券市场的成交量加权平均交易价格在连续三十个交易日内的任何二十个交易日内(以下简称“交易价格")大于或等于12.50美元,盈利卖方将有权获得总计15000000股盈利股票乘以所购股票百分比; |
37
| b) | 如果在盈利期内,交易价格高于或等于15.00美元,则盈利期卖方将有权获得总计18,000,000股额外盈利期股票乘以所购股票百分比;以及 |
| c) | 如果在盈利期内的任何时间和当日,交易价格高于或等于17.50美元,则盈利卖方将有权获得总计21,000,000股额外盈利股份乘以所购股份百分比。 |
如果在盈利期内,合并后公司的控制权发生变更,据此合并后公司或其股东有权收取对价,该对价意味着A类普通股的每股价值等于或超过一个或多个触发事件所依据的交易价格,那么,在此控制权变更完成之前,(i)在相关触发事件以前未曾发生的范围内,此类相关触发事件应被视为已经发生,并且(ii)每个盈余卖方应有权根据被视为发生的适用触发事件获得其所发行的适用盈余股票数量的按比例份额。
附属协定
锁定协议
在执行和交付《企业合并协议》的同时,某些GIO股东(“GIO内部人士”)同意,除某些惯例例外情况外,不得(i)出借、要约、质押、质押、抵押、担保、捐赠、转让、出售、合同出售、出售任何购买期权或合同、购买任何出售期权或合同、授予购买ACIC A类普通股的任何股份的任何期权、权利或认股权证,或以其他方式直接或间接转让或处置ACIC A类普通股的任何股份,(ii)订立全部或部分转让给另一方的任何互换或其他安排,ACIC A类普通股所有权的任何经济后果,或(iii)公开披露上述任何一项的意图,直至交易结束一年后的日期。如果从收盘后第180天开始,ACIC A类普通股的交易价格大于或等于12.00美元,则此类限制将失效。
投票协议
在执行和交付业务合并协议的同时,ACIC和GIO订立了GIO Insiders的投票协议(“投票协议”)。根据投票协议,GIO Insiders同意将其持有的所有GIO普通股投票赞成业务合并协议、由此设想的交易以及将提交GIO股东批准的某些其他相关事项。GIO Insiders还同意采取某些其他行动来支持业务合并协议和相关交易,并且不采取会对这些GIO Insiders履行投票协议义务的能力产生不利影响的行动。投票协议还禁止GIO内部人士在投票协议日期至截止日期之间转让GIO股份,但投票协议中规定的某些允许转让除外。
非竞争协定
在执行和交付《企业合并协议》的同时,GIO的某些股东(每个股东,一个“GIO高管”)签订了一项非竞争和非邀约协议(“非竞争和非邀约协议”),在交割时生效,根据该协议,他们同意,在交割后的三年期间,他们将不会(i)推广以干细胞为基础的献血替代品;(ii)推广以干细胞为基础的美容护肤产品;(iii)经营提供抗衰老干细胞为基础的治疗的诊所(印度、墨西哥除外,哥斯达黎加和GIO主题缔约方的附属机构目前在《企业合并协议》签署之日参与此类治疗的美国城市),或(iv)参与COVID后干细胞治疗的临床试验。
卖方登记权协议
在执行和交付业务合并协议的同时,GIO Insiders签订了一份登记权协议,自交割之日起生效。根据该协议,ACIC将向GIO Insiders提供登记权,涉及(i)在交割时作为对价向GIO Insiders发行的ACIC A类普通股和(ii)他们在交割后收到的任何盈利股份。
38
组织Structure
下图描述了GIO当前组织结构的简化版本。

附加信息
如需更多信息,包括有关美国联邦所得税对美国公共股东的某些重大影响以及与企业合并有关的其他协议的信息,请参阅本代理声明/招股说明书中题为“提案1:企业合并提案”的部分。
提案2:NTA提案
ACIC要求其股东批准一项提案,修改ACIC经修订和重述的公司注册证书,以取消限制ACIC赎回A类普通股的能力的要求,并完成初始业务合并,前提是此类赎回的金额将导致ACIC的有形资产净值低于5,000,001美元。
我们鼓励股东仔细考虑下面“第2号提案—— NTA提案”中列出的信息。
提案3:《宪章》提案
关于企业合并,ACIC要求其股东批准一项修改和重申现行章程的提案。拟议的《宪章》将在企业合并完成后生效。拟议章程(i)载有与因故罢免董事、修订拟议章程的董事人数和董事任期条款以及修订拟议章程的股东条款有关的绝对多数表决条款;(ii)规定股东特别会议只能由合并公司董事会召集,或由合计拥有股东的在册股东要求召开,(iii)不包括股东通过书面同意采取行动的权利;(iv)不包括在完成业务合并时不需要的某些空白支票条款;(v)在交割后将ACIC的名称更改为“GIO World Health Holdings,Inc.”;(vi)规定合并后的公司将被授权发行的股本数量与根据现行章程授权的数量相比有所增加。
章程提案载于本委托书/说明书题为“提案3:章程提案”的一节。
拟议《宪章》在重大方面与现行《宪章》不同,行政协调会促请股东仔细查阅题为“提案3:《宪章》提案”一节中所载的资料和作为附件B附的《拟议《宪章》全文。
如需更多信息,请参阅本代理声明/招股说明书中题为“提案3:章程提案”的部分。
39
提案4 – 9:组织文件提案
ACIC的股东还被要求在不具约束力的咨询基础上批准《组织文件提案》,这些提案涉及《拟议宪章》中的某些公司治理条款,如果《拟议宪章》提案获得批准,这些条款将结合《拟议宪章》获得通过。这些单独的投票不是特拉华州法律所要求的,而是美国证交会要求股东有机会就重要的公司治理条款发表意见的指导意见所要求的。业务合并不以单独核准组织文件提案为条件。
组织文件建议与拟议章程有关:(一)包括与因故罢免董事、修订拟议章程的董事人数和董事任期条款以及修订拟议章程的股东有关的绝对多数表决标准;(二)规定股东特别会议只能由合并后的公司董事会召集,或由合计拥有股份的在册股东要求召开,(iii)不包括股东通过书面同意采取行动的权利;(iv)不包括在完成业务合并时不需要的某些空白支票条款;(v)在交割后将ACIC的名称更改为“GIO World Health Holdings,Inc.”;(vi)规定合并后公司将被授权发行的合并后公司股本的股份数量与根据现行章程授权的股份数量相比有所增加。
如需更多信息,请参阅本代理声明/招股说明书中题为“提案4-9:组织文件提案”的章节。
建议10:奖励计划建议
假设企业合并提案和章程提案获得批准,ACIC的股东也将被要求批准激励计划提案。
ACIC股东应仔细阅读整个激励计划,其形式作为附件D附在本委托书/招股说明书中,然后再对此提案进行表决。该激励计划提案将提交ACIC股东审议和投票。
如需更多信息,请参阅本代理声明/招股说明书中题为“提案10:激励计划提案”的部分。
提案11:董事选举提案
合并后的公司董事会将由七名董事组成,其中包括GIO在合并前指定的五名董事,其中至少三名符合适用规定的独立董事和ACIC在合并前指定的两名董事,其中至少一名符合适用规定的独立董事,在合并后的公司董事会任职至下一次股东年会,以选举该董事所任职的董事类别,直至其继任者正式当选并符合资格为止,或直至其死亡、辞职、撤职或丧失资格为止。ACIC提议股东批准在合并完成后选举七名被提名的董事担任合并后的公司董事会成员。董事选举提案正提交ACIC股东审议和表决。
如需更多信息,请参阅本委托书/招股说明书中题为“提案11:董事选举提案”的部分。
提案12:休会提案
休会提案允许行政协调会理事会提交一项提案,核准将特别会议休会至更晚的日期,必要或适当时,由行政协调会理事会决定。如果将休会提案提交给公众股东,将提交审议和表决。
如需更多信息,请参阅本代理声明/招股说明书中题为“提案12:延期提案”的部分。
40
特别会议的日期、时间和地点
特别会议将于美国东部时间2023年[·]上午[·]在https://www.cstproxy.com/[·]通过网络直播举行,审议并表决将提交特别会议的各项提案,包括必要或可取的休会提案。
可通过以下网址访问特别会议:https://www.cstproxy.com/[·],在那里你可以收听现场会议并在会议期间投票。请注意,你只能通过远程通讯方式参加特别会议。请出示你的控制号码,号码可在你的代理卡上找到,以便参加特别会议。
登记参加特别会议
如果你是注册股东,你收到了大陆集团的代理卡。该表单包含有关如何参加虚拟特别会议的说明,包括URL地址以及您的控制号码。你需要你的控制号码才能进入。如果您没有自己的控制号码,请致电917-262-2373与大陆集团联系,或发送电子邮件至proxy@continentalstock.com。
你可以预先登记参加东部时间2023年[·]上午[·]开始的特别会议。在浏览器中输入URL地址https://www.cstproxy.com/[·],输入控制号、姓名和电子邮件地址。一旦你预先登记,你就可以投票你的股份。在特别会议开始时,你需要使用你的控制号码重新登录,如果你在特别会议期间投票,也会提示你输入你的控制号码。
通过银行、经纪人或其他代名人拥有其投资的受益所有人需要联系大陆集团以获得一个控制号码。如果您打算在特别会议上投票,您需要有您的银行、经纪人或其他代名人的法定代理人,或者如果您想加入而不是投票,大陆集团将向您发出带有所有权证明的客人控制号码。无论哪种方式,您都必须联系大陆集团,了解如何接收控制号码的具体说明,请使用上面的号码或电子邮件地址。请在特别会议召开前最多留出72小时处理你的控制号码。
如果您没有互联网功能,您只能通过在美国或加拿大境内拨打[·]或在美国和加拿大境外拨打[·]收听特别会议(适用标准费率);当出现提示时,请输入密码[·]。这是只听,你将不能在特别会议期间投票或进入问题。如果你亲自出席特别会议,你将能够与其他股东沟通,并在特别会议上投票。
投票权;记录日期
如果公众股东在2023年[·],即特别会议的记录日期(“记录日期”)营业结束时持有普通股,他们将有权在特别会议上投票或直接投票。在记录日期营业结束时,公众股东将对所持ACIC普通股的每一股拥有一票表决权。如果你的股票是以“街道名称”持有的,或者是保证金或类似的账户,你应该联系你的银行、经纪人或其他代名人,以确保与你实益拥有的股票相关的投票被正确计算。ACIC的认股权证没有投票权。在记录日期,共有5,814,703股ACIC普通股已发行和流通,其中4,312,500股由保荐人持有。
股东的法定人数和投票
要召开一次有效的会议,ACIC的股东必须达到法定人数。如果有权在特别会议上投票的所有已发行和未发行的ACIC普通股的持有人亲自或通过代理人代表,代表所有已发行和未发行的ACIC普通股的多数投票权,则出席特别会议的法定人数即为法定人数。弃权票和中间人不投票,虽然为确定法定人数而被视为出席,但不计入在特别会议上所投的票。截至特别会议的记录日期,总共需要2,907,352股ACIC普通股(按转换后的基准)才能达到法定人数,作为一个单一类别一起投票。
拥有ACIC已发行和流通普通股74.2%股份的保荐人,此前已同意将其所有普通股投票支持提交给他们审批的企业合并,包括企业合并。此外,内部人士及其关联公司已同意对他们拥有的任何普通股进行投票,以支持企业合并。
41
在特别会议上,每项提案均需获得以下表决:
| ● | 业务合并提案:企业合并提案要求获得在特别会议上投票的ACIC普通股多数股东的赞成票。 |
| ● | NTA提案:NTA提案必须获得作为单一类别共同投票的ACIC普通股多数股东的赞成票才能通过。 |
| ● | 宪章提案:《章程》提案必须获得持有ACIC普通股类别多数股份的股东(包括持有B类股份多数股份的股东,作为一个单独类别共同投票)的赞成票。 |
| ● | 组织文件提案:组织文件提案,每一项都是不具约束力的咨询投票,必须得到已发行ACIC普通股多数股东的赞成票。 |
| ● | 奖励计划提案:激励计划提案要求获得在特别会议上投票的ACIC普通股多数股东的赞成票。 |
| ● | 董事选举提案:选举被提名的董事需要出席特别会议或由代理人代表出席特别会议的ACIC普通股股东的多数票。“多元化”指的是,获得“赞成”票数最多的个人当选为董事。 |
| ● | 休会提案:暂停提案要求获得在特别会议上投票的ACIC普通股多数股东的赞成票。 |
对于本委托书/招股说明书中的每一项提案,您可以投“赞成”、“反对”或“弃权”票。
如果股东未交回代理卡,或未指示经纪人或其他代名人如何投票,且未亲自出席特别会议,则该股东的股份将不计算在内,以确定出席特别会议的人数是否达到法定人数。
在确定是否确定有效的法定人数时,将计算弃权票和非中间人投票,但不会对任何提案产生影响。
赎回权
根据现行章程,如果企业合并完成,公众股东可要求ACIC将该公众股东的全部或部分公众股份赎回为现金。只有在以下情况下,你方有权获得赎回任何公众股份的现金:
| a) | 持有公众股份或透过ACIC单位持有公众股份,而你在行使有关公众股份的赎回权前,选择将你的ACIC单位分离为基础公众股份及认股权证;及 |
| b) | 美国东部时间下午5时前,在[·]、2023年(特别会议投票前两个工作日)(或ACIC自行决定批准的较后日期),(i)向转让代理提交书面请求,要求ACIC以现金赎回您的公众股份,以及(ii)通过DTC以实物或电子方式将您的股票证书(如有)和其他赎回表格交付给转让代理。 |
如上所述,ACIC单位的持有人在行使公众股份的赎回权之前,必须选择将基础公众股份和公开认股权证分开。持有人可以指示其银行、经纪人或其他代名人这样做,或者,如果持有人持有以自己的名义注册的ACIC单位,持有人必须直接与转让代理联系并指示其这样做。
公众股东可以选择赎回其全部或部分公众股份,无论他们是否投票赞成或反对企业合并提案。如果企业合并未完成,公众股份将不会被赎回为现金。如公众股东适当行使其赎回其公众股份的权利,并及时交付其股票(如有的话)及其他
42
向转让代理发出赎回表格,ACIC将按每股价格赎回每一股该等公众股份,以现金支付,金额相当于在企业合并完成前两个营业日存入信托账户的总金额,包括信托账户资金所赚取的利息(以前未发放给ACIC用于纳税)除以当时已发行的公众股份的数量。截至2023年[·],这一数额约为每股公股[·]美元。
如果公众股东行使其赎回权,那么它将用其赎回的公众股份换取现金,并且将不再拥有这些股份。任何赎回要求一经提出,可随时撤回,直至要求赎回的截止日期,其后经ACIC同意,直至企业合并完成,或ACIC董事会确定的其他日期。持有人可通过联系转让代理提出此种请求,地址或电子邮件地址列于本代理声明/说明书中。只有在要求赎回的截止日期之前,ACIC才会被要求履行这一要求。请参阅“股东特别会议----赎回权”,详细说明如果你想用现金赎回你的公众股份,应该遵循的程序。
尽管有上述规定,公众股东,连同该公众股东的任何附属机构或与该公众股东一致行动的任何其他人,或作为一个“团体”(如《交易法》第13条所定义),将被限制赎回其公众股份,不得超过公众股份总数的15%。因此,如果公众股东单独或一致行动或作为一个集团寻求赎回超过15%的公众股份,则超过15%限制的任何此类股份将不会被赎回为现金。
为使公众股东就企业合并建议行使其赎回权,公众股东必须在美国东部时间2023年[·]下午5:00(特别会议投票前两个工作日)(或ACIC自行决定批准的较晚日期)之前适当行使其赎回其持有的公众股份的权利,并将其股票(如有)和其他赎回表格(实物或电子形式)交付给转让代理。在企业合并完成后,ACIC将通过赎回发行给有效行使赎回权的公众股东的公众股份来满足赎回权的行使。
ACIC认股权证的持有人将不会对任何认股权证(包括任何基于认股权证的普通股)拥有赎回权。
评估权
ACIC的股东不享有与DGCL下的业务合并有关的评估权。
代理征集
代理人可以通过邮件、电话或亲自征集。ACIC已聘请[·]协助征集代理人。
如果股东授予代理人,如果股东在特别会议前撤销其代理人,股东仍可亲自投票表决其股份。股东还可以提交一份较晚日期的委托书,如题为“特别会议——撤销你的委托书”一节中所述,从而改变其投票。
ACIC的内部人、管理人员和董事在业务合并中的利益
在考虑ACIC董事会对企业合并投赞成票的建议时,公众股东应该意识到,除了作为股东的利益之外,ACIC的内部人士在企业合并中的利益与ACIC的公众股东的利益不同,或者除了这些利益之外。ACIC的董事在评估企业合并以及向ACIC的股东建议他们批准企业合并时,都意识到并考虑了这些利益。公众股东在决定是否批准企业合并时应考虑到这些利益。除其他外,这些利益包括:
| ● | 保荐人持有4312500股创始人股份,这些股份是以25000美元的总价从ACIC购买的,如果合并完成,这些股份在企业合并时的价值会高得多,根据ACIC普通股在2023年5月9日的收盘价10.50美元计算,在同一日期的总价值约为4530万美元。如果ACIC没有在2023年8月14日之前完成业务合并或其他初始业务合并,因此ACIC被要求清算,这些股份将一文不值,因为Founder Shares无权参与信托账户的任何赎回或清算。基于 |
43
| 保荐人为创始人股份支付的实际购买价格为每股0.006美元,与首次公开发行中每单位10.00美元的购买价格相比,即使合并后公司的股价在收盘后低于首次公开发行中为ACIC单位最初支付的价格,并且ACIC公众股东在企业合并结束后经历负回报率,保荐人仍可获得正回报率; |
| ● | 保荐人以每份私人认股权证1.00美元购买的8,200,000份私人认股权证,如果不能完成业务合并,这些认股权证将一文不值(尽管私人认股权证的某些权利与公开认股权证持有人的权利不同,假设私人认股权证的每份认股权证价值与公开认股权证2023年5月9日在OTCM上的0.04美元收盘价相同,保荐人持有的8,200,000份私人认股权证的总价值估计约为328,000美元); |
| ● | 如果ACIC无法完成其初始业务合并,ACIC的内部人士已放弃在ACIC清算时赎回其创始人股份及其持有的任何其他普通股的权利,或从信托账户获得有关创始人股份的分配; |
| ● | 除非ACIC完成初始业务合并,否则其董事和高级管理人员将不会获得补偿,以补偿他们因业务合并而产生的任何自付费用(只要这些费用超过未存入信托账户的可用收益的数额)。截至[·],2023年,ACIC的任何董事或高级职员都没有发生任何他们预期在交易结束时得到补偿的费用; |
| ● | 继续向ACIC现任董事和高级职员提供赔偿,并在业务合并后继续提供董事和高级职员责任保险; |
| ● | 内部人可能被激励完成企业合并,或与不那么有利的公司进行替代的初始企业合并,或以对股东不那么有利的条件进行清算,而不是清算,在这种情况下,内部人将损失其全部投资。因此,内部人士在确定GIO是否是与之进行业务合并的适当企业和/或在评估业务合并的条款方面可能存在利益冲突;以及 |
| ● | 预计在业务合并完成后,ACIC首席执行官、总裁兼董事长Joel Shulman博士将被选举为合并后公司的董事。因此,在未来,该董事将获得合并后的公司董事会决定支付给其董事的任何现金费用、股票期权或股票奖励。 |
在特别会议之前的任何时间,在他们不知道有关ACIC或ACIC证券的任何重大非公开信息的时期内,ACIC的内部人士和GIO或他们各自的关联公司可以从投资者那里购买公众股份或公开认股权证,或者他们可以与这些投资者和其他人进行交易,为他们提供激励,以购买公众股份或投票支持企业合并提案,或撤回任何赎回请求。在这种交易中,购买公众股份的价格将不超过赎回价格。此外,根据内幕信息交易协议的条款,上述人士将放弃对其在此类交易中获得的公众股份的赎回权(如果有的话)。然而,上述人士取得的任何公众股份将不会就企业合并建议进行表决。
这种股份购买和其他交易的目的是增加完成业务合并的条件得到满足的可能性。这可能会导致我们的业务合并的完成,而这本来是不可能的。尽管截至本代理声明/招股说明书发布之日,任何此类激励措施的确切性质尚未确定,但它们可能包括但不限于保护此类投资者或持有人免受其股票价值潜在损失的安排,包括授予看跌期权。
订立任何该等奖励安排,可能对公众股份有抑制作用。例如,由于这些安排,投资者或持有者可能有能力以低于市场的价格有效购买股票,因此可能更有可能在特别会议之前或之后立即出售其所拥有的股票。
截至本代理声明/招股说明书之日,尚未进行过此类讨论,也未与任何此类投资者或持有人达成任何此类协议。如果订立此类安排或协议,ACIC将在特别会议之前提交一份8-K表格的当前报告,以披露上述任何人订立的任何安排或进行的重大采购。任何该等报告将包括(i)购买的公众股份数目及购买价格;(ii)
44
此种购买的目的;(iii)此种购买对企业合并交易获得批准的可能性的影响;(iv)未在公开市场购买而出售股票的证券持有人的身份或特征或卖方的性质;(v)ACIC收到赎回请求的公众股票的数量。
ACIC董事和高级管理人员的财务和个人利益的存在可能导致利益冲突,包括在决定建议股东投票支持提案时,符合公司及其股东最佳利益的事项与符合董事个人利益的事项之间的冲突。有关更多信息和其他风险,请参见标题为“风险因素”、“提案1:业务合并提案—— ACIC的保荐人、董事和高级管理人员及其他人员在业务合并中的权益和“证券的实益所有权”和“提案1:业务合并提案—— ACIC董事会的建议和业务合并的原因”的章节。
业务合并中的某些其他权益
除了ACIC的内部人士在企业合并中的利益外,ACIC的股东还应该意识到,Cantor可能拥有与ACIC股东的利益不同或不同的财务利益,包括Cantor及其指定人员拥有75万份私人认股权证,这些认股权证由Cantor以每份私人认股权证1.00美元的价格购买,如果企业合并不能完成,这些认股权证将一文不值。虽然私人认股权证的某些权利不同于公共认股权证持有人的权利,但Cantor或其指定人员持有的750,000份私人认股权证的总价值估计约为[·]美元,假设私人认股权证的每份认股权证价值与公开认股权证在2023年[·]日在OTCM上的收盘价[·]美元相同。
行政协调会理事会的建议
ACIC董事会认为,将在特别会议上提交的企业合并提案和其他提案符合ACIC的最佳利益,并建议ACIC的股东投票支持“企业合并提案”、“支持”NTA提案、“支持”章程提案、“支持”单独的组织文件提案、“支持”激励计划提案、“支持”董事选举提案,如果在特别会议上提交,“支持”休会提案。
完成业务合并的条件
有关完成业务合并的条件的讨论,请参阅“提案1:业务合并提案”。
美国联邦所得税后果
有关行使赎回权和企业合并的美国联邦所得税考虑,请参阅“提案1:企业合并提案——企业合并对ACIC股东的重大美国联邦所得税后果”。
预期会计处理
有关对企业合并的预期会计处理进行总结的讨论,请参阅“提案1:企业合并提案——赎回的重大美国联邦所得税后果——预期会计处理”。
监管事项
除根据适用于ACIC的报告要求以及《证券法》和《交易法》的要求向SEC提交的文件外,企业合并和《企业合并协议》所设想的交易不受任何额外监管要求或批准的约束,包括提交本委托书/招股说明书所构成的登记声明以及向ACIC股东分发本委托书/招股说明书的要求。
45
风险因素摘要
在决定如何投票支持本代理声明/招股说明书中提出的建议时,你应考虑本代理声明/招股说明书中所载的所有信息。特别是,您应该考虑在“风险因素”一节中描述的风险因素。这些风险包括但不限于在业务合并后与本公司有关的下列风险:
与业务合并有关的风险
| ● | 由于ACIC股东对大量公众股份行使赎回权的能力或其他因素,ACIC可能无法完成业务合并或优化其资本结构。 |
| ● | 对于非保荐人关联公司的ACIC股东而言,存在通过业务合并而不是通过承销公开发行直接购买GIO证券而成为合并后公司股东的风险,包括承销商不进行独立的尽职审查。 |
| ● | 由于ACIC的内部人士将失去他们在ACIC的全部投资,如果企业合并或替代企业合并没有完成,并且由于ACIC的保荐人、执行官员和董事将没有资格获得补偿,如果企业合并没有完成,在确定GIO是否适合ACIC的初始企业合并时,可能会产生利益冲突。 |
| ● | 企业合并完成后,创始人股份的价值很可能大大高于为这些股份支付的名义价格,即使当时合并公司普通股的交易价格大大低于每股10.00美元。 |
| ● | 保荐人、GIO或其各自的关联机构可以选择从ACIC的公众股东手中购买普通股或公开认股权证,这可能会影响对拟议的初始业务合并的投票,并减少ACIC普通股的公众“持股量”。 |
与合并后公司普通股所有权相关的风险
| ● | 合并后公司证券的活跃市场可能不会发展,这将对合并后公司证券的流动性和价格产生不利影响。 |
| ● | 不能保证将就企业合并而发行的合并公司普通股股票在收盘后将获准在适当的市场或交易所上市。 |
| ● | 合并后公司的股价可能会在合并后发生重大变化,你可能会因此损失全部或部分投资。 |
| ● | 你目前作为ACIC股份持有人的权利与作为合并公司普通股持有人的权利之间将存在重大差异,其中一些可能会对你产生不利影响。 |
| ● | 合并后的公司可在行使认股权证之前赎回未到期的公开认股权证,时间对认股权证持有人不利。 |
与赎回有关的风险
| ● | 不能保证ACIC公众股东决定是否按比例赎回其普通股,以换取信托账户的一部分,将使该股东处于更有利的未来经济地位。 |
| ● | 如果ACIC公众股东未能遵守本委托书/招股说明书中规定的赎回要求,他们将无权按信托账户所持资金的比例赎回其公众股份。 |
46
与ACIC相关的风险
| ● | 如果第三方对ACIC提出索赔,信托账户中的收益可能会减少,公众股东收到的赎回价格可能低于每股[ • ]美元。 |
| ● | 如果根据经修订的1940年《投资公司法》,ACIC被视为“投资公司”投资公司法"),我们可能被要求制定繁琐的合规要求,我们的活动可能受到限制,这可能使ACIC难以完成业务合并。 |
与GIO相关的风险
| ● | GIO尚未开始计划中的业务项目活动,也没有将Treatments商业化的历史,这可能使其难以评估其未来可行性的前景。 |
| ● | GIO计划在风险和不确定性较高、难以评估GIO未来潜在价值和前景的行业和领域开展多项业务。 |
| ● | GIO可能无法建立其计划的部分或全部业务线,或者如果它能够建立和执行这些业务线,则部分或全部业务线可能不会成功。 |
| ● | GIO预计,其治疗的开发将需要大量的时间和物质资源,而GIO可能无法获得这些资源。 |
| ● | GIO未来潜在的抗衰老诊所业务能否成功,可能部分或完全取决于第三方诊所所有者/经营者。 |
| ● | GIO将需要获得大量资金来执行其目前的业务线计划,如果有的话,GIO可能无法以可接受的条件获得这些资金。 |
| ● | GIO的某些管理人员和董事由于在GIOSTAR或其他业务中的利益或职位,可能与他们对GIO的责任或与GIO的责任存在实际或潜在的利益冲突。 |
| ● | 如果对GIO的Treatments的需求低于GIO的预期,GIO从计划的Treatment产品中获得收入的能力可能会受到不利影响,GIO的业务可能不会实现,或者可能会受到影响。 |
| ● | 如果GIO无法安排设计和制造能够生产其通用红细胞的生物反应器,通用红细胞业务可能不会成功。 |
| ● | 科学、安全和临床试验以及监管和营销审批过程可能是漫长和昂贵的,而且不能保证GIO的任何治疗将证明其预期用途或目的的有效性,也不能保证GIO的任何此类努力,或GIO可能产生的相关费用,将为GIO带来有利的结果。 |
| ● | 如果GIO不能及时或根本不能完成其部分或全部治疗的开发、获得适用的监管批准和商业化,其业务将受到损害。 |
| ● | 如果GIO的任何疗法导致严重的不良事件、不良副作用或意外特征,这些事件、副作用或特征可能会延迟或阻止监管机构批准此类疗法或其未来开发的其他疗法,导致负面新闻报道,限制其商业潜力,或对GIO及其前景造成其他重大负面后果。 |
| ● | GIO的商业成功有赖于其Treatments(如果获得批准)在患者、客户、诊所运营商以及(在某些情况下)化妆品和涉及抗衰老产品的公司中获得巨大的市场认可,而GIO可能无法成功获得这种市场认可。 |
47
| ● | 随着GIO开始业务线活动,可能会出现新的和不可预见的挑战、风险和费用,这些挑战、风险和费用可能很大,GIO的计划可能会以目前无法预见或预期的方式发生变化,GIO的招股说明书和业绩可能会受到影响。 |
| ● | 在技术快速变化的环境中,GIO可能面临重大竞争,其竞争对手可能会先于GIO获得监管批准,或开发出比GIO更安全、更先进或更有效的Treatments,这可能会损害GIO的财务状况及其成功营销或商业化其Treatments的能力。 |
| ● | GIO可能无法保护其知识产权,导致其业务受损。 |
| ● | GIO的Treatments非常复杂,很难制造,除非它能够开发出必要的内部能力。GIO将依赖第三方制造商来制造和供应其Treatments或其组件。 |
| ● | GIO可能在满足监管当局要求方面遇到延误,或出现生产问题,从而导致其开发或商业化计划的延误,限制其Treatments的供应,或以其他方式损害其业务。 |
| ● | GIO的声誉一旦确立,就可能难以维持,其开发的任何疗法的市场接受度可能会波动或下降,这在一定程度上是由于全球各相关地区的公众对人类干细胞与此类疗法相关的使用的看法。 |
| ● | GIO Treatments的监管环境尚不确定;与更成熟的干细胞疗法相关的法规仍在制定中,监管要求的变化可能会导致GIO Treatments的开发延迟或停止,或导致获得监管批准的意外成本。FDA和其他管理机构可能不同意GIO的监管计划,也可能无法获得GIO Treatments的监管批准。 |
| ● | GIO发展业务的能力高度依赖于第三方许可的知识产权,终止任何此类安排都可能导致重大权利的丧失,从而损害其业务。 |
| ● | GIO获得上市批准的任何治疗都可能受到限制或退出市场,如果GIO未能遵守监管要求,或在药物获得批准时或如果药物出现意外问题,GIO可能会受到重大处罚。 |
| ● | 医疗保健和其他改革立法可能会增加GIO和任何合作者的难度和成本,GIO可能必须获得GIO可能开发的任何疗法的营销批准并将其商业化,并可能影响GIO或他们可能为商业化疗法获得的价格或收入。 |
| ● | GIO未来可能在美国境外建立、参与或维持的任何业务的法律和法规可能会阻止GIO在GIO原本希望运营的司法管辖区开发、制造和销售某些Treatment,并要求GIO开发和实施成本高昂的合规项目以实现其业务目标。 |
| ● | 如果GIO失去关键的管理或科研人员,或者未能招聘更多的高技能人员,GIO开发、识别和开发Treatments的能力将受到损害,这可能导致开发过程的延迟,失去市场机会,降低GIO的竞争力,并对GIO的未来前景、业务、财务状况和经营业绩产生重大不利影响。 |
48
摘要未经审计的合并财务信息
以下未经审计的简明合并财务数据摘要(“备考资料摘要”)适用于业务合并所设想的交易(“交易”)。根据公认会计原则,该业务合并将作为反向合并入账。在这种会计方法下,尽管ACIC将收购GIO在企业合并中的所有未偿股权,但出于财务报告目的,ACIC将被视为“被收购”公司。因此,业务合并将反映为相当于合并后的公司以ACIC的净资产发行股份,然后进行资本重组,不记录商誉或其他无形资产。业务组合之前的操作将是GIO的操作。截至2022年12月31日的未经审计的简明合并资产负债表摘要使这些交易生效,就好像它们发生在2022年12月21日一样。截至2022年12月31日止年度未经审计的简明合并经营报表摘要使这些交易生效,就好像它们发生在2022年1月1日一样。
本报告概要资料源自本委托书/招股说明书及其附注中题为“未经审计的备考简明合并财务资料”一节中更详细的未经审计的备考简明合并财务资料,应与之一并阅读。未经审计的备考简明合并财务信息以本代理声明/招股说明书所载适用期间的历史财务报表及ACIC和GIO的相关说明为基础,并应与之一并阅读。临时形式资料摘要仅供参考,并不一定表明如果在所示日期完成业务合并,合并后公司的财务状况或业务结果实际上会是什么情况。此外,简要形式资料无意预测合并后公司在反向合并后的未来财务状况或经营成果。
未经审计的简明合并财务资料是根据以下关于可能将普通股赎回为现金的假设编制的:
| ● | 假设没有赎回:本演示文稿假定,在企业合并完成后,ACIC的任何公众股东均不对其公众股份行使赎回权。 |
| ● | 假设BCA最大赎回:这一列报假定:(一)326881股公众股赎回,赎回付款总额为340万美元,假定根据截至2023年4月30日信托账户的资金计算的每股赎回价格为10.47美元;(二)如果ACIC在收盘时没有现金或现金等价物,拟议的业务合并将不会完成,包括信托账户中的剩余资金(在完成和支付赎回款项后)和任何交易融资的收益,至少相当于在交易结束时支付ACIC和GIO的估计交易费用和负债所需的数额费用条件,”如下文进一步描述)。由于ACIC的所有Insiders在ACIC IPO时都放弃了赎回权,本演示文稿中只反映了公众股东的赎回。这一设想方案包括“无赎回”设想方案中所载的所有调整,并提出额外的调整,以反映《巴塞尔公约》最大赎回的影响,同时考虑到费用条件。“BCA最大赎回情形”(i)假设NTA提案在特别会议上获得ACIC股东的批准,并且(ii)代表在满足费用条件的情况下可赎回的最大公众股份数量;但是,前提是根据业务合并协议的条款,费用条件不是完成交易的合同条件,并且业务合并可以在不满足费用条件的情况下按照合同交易条款完成。如果企业合并在费用条件未得到满足的情况下完成(或者,如果估计的交易费用或任何交易融资的收益(如果有的话)导致在截止日期的费用条件与本BCA最大赎回情景演示文稿中包含的假设不同),最多可赎回“BCA最大赎回情景”中所反映的1175322股公众股票。 |
49
每股比较资料
下表列出了ACIC和GIO的历史股份比较信息摘要以及交易生效后ACIC未经审计的合并每股合并信息,在两种假设的赎回情形下列示如下:
| ● | 假设没有赎回:本演示文稿假定ACIC的任何公众股东都不对其公众股份行使赎回权。 |
| ● | 假设BCA最大赎回:这一列报假定:(一)326881股公众股赎回,赎回付款总额为340万美元,假定根据截至2023年4月30日信托账户的资金计算的每股赎回价格为10.47美元;(二)如果ACIC在收盘时没有现金或现金等价物,拟议的业务合并将不会完成,包括信托账户中的剩余资金(在完成和支付赎回款项后)和任何交易融资的收益,至少相当于在交易结束时支付ACIC和GIO的估计交易费用和负债所需的数额费用条件,”如下文进一步描述)。由于ACIC的所有Insiders在ACIC IPO时都放弃了赎回权,本演示文稿中只反映了公众股东的赎回。这一设想方案包括“无赎回”设想方案中所载的所有调整,并提出额外的调整,以反映《巴塞尔公约》最大赎回的影响,同时考虑到费用条件。“BCA最大赎回情形”(i)假设NTA提案在特别会议上获得ACIC股东的批准,并且(ii)代表在满足费用条件的情况下可赎回的最大公众股份数量;但是,前提是根据业务合并协议的条款,费用条件不是完成交易的合同条件,并且业务合并可以在不满足费用条件的情况下按照合同交易条款完成。如果企业合并在费用条件未得到满足的情况下完成(或者,如果估计的交易费用或任何交易融资的收益(如果有的话)导致在截止日期的费用条件与本BCA最大赎回情景演示文稿中包含的假设不同),最多可赎回“BCA最大赎回情景”中所反映的1175322股公众股票。 |
选定的截至2022年12月31日的未经审计的备考简明合并账面价值信息对交易和其他事项的备考影响就好像在2022年1月1日完成一样。选定的截至2022年12月31日止年度未经审计的合并每股净收益(亏损)和加权平均已发行股份合并报表信息对交易和与业务合并相关的其他事件具有备考效果,就好像在2022年1月1日完成一样,即最早呈报期间的开始。
此信息仅为摘要,应与本代理声明/招股说明书其他部分所载的ACIC和GIO的历史财务报表及附注一并阅读。ACIC和GIO的未经审计的备考简明合并每股信息来自本委托书/说明书/招股说明书中题为“未经审计的备考简明合并财务报表”一节中其他部分的未经审计的备考简明合并财务信息和附注,应与之一并阅读。
以下未经审计的合并每股收益(亏损)信息不是指如果在报告所述期间将两家公司合并,可能产生的每股收益(亏损),也不是指任何未来日期或期间的每股收益。以下未经审计的合并后每股账面价值信息并不代表如果在报告所述期间将这两家公司合并的话,ACIC和GIO的价值将是多少。
50
ACIC提供以下每股比较信息,以帮助您分析交易的财务方面。
预估合并 |
||||||||||||
截至2022年12月31日止年度 |
|
ACIC |
|
GIO |
|
假设没有 |
|
假设 |
||||
净收入/(亏损) |
$ |
6,582,898 |
$ |
(242,096) |
$ |
2,638,674 |
$ |
2,638,674 |
||||
股东权益(赤字) |
$ |
(11,662,442) |
$ |
29,701 |
$ |
966,141 |
$ |
(2,456,943) |
||||
每股股东权益(亏损)–基本及摊薄 |
$ |
(0.55) |
$ |
— |
$ |
0.03 |
$ |
(0.08) |
||||
现金股利 |
$ |
— |
$ |
— |
$ |
— |
$ |
— |
||||
加权平均股----基本股和稀释股 |
21,043,342 |
— |
29,382,858 |
29,055,977 |
||||||||
每股净亏损----基本亏损和摊薄亏损 |
$ |
0.31 |
$ |
— |
$ |
0.09 |
$ |
0.09 |
||||
每股股东权益=总股本/已发行股份
51
市场价格和股息信息
ACIC
股票代码和市场价格
ACIC单位、普通股和认股权证分别在场外交易市场交易,交易代码分别为“APNCU”、“APNC”和“APNCW”。ACIC Units于2021年11月9日开始公开交易,其普通股和认股权证分别于2021年12月30日开始公开交易。2023年1月31日,ACIC收到纽约证交所员工的书面通知,称其不符合《纽约证交所上市公司手册》第802.01B节的规定,该节要求一家上市公司在连续30个交易日内保持其公开持股的全球平均总市值至少为40,000,000美元。因此,这些公开发行的证券从纽约证券交易所退市。退市后,ACIC单位、普通股和认股权证开始在OTCM公开交易。
ACIC单位由一股普通股和半份认股权证(每份整份认股权证赋予其持有人购买一股普通股的权利)组成,在业务合并完成后将自动分离为其组成证券,在交易结束后ACIC证券将不再交易。截至记录日期,ACIC单位、普通股和公开认股权证的收盘价分别为[·]美元、[·]美元和[·]美元。ACIC公开认股权证持有人和不选择赎回其公开认股权证的股东无需将其公开认股权证或公开认股权证证书交付ACIC或ACIC的转让代理,他们将在交割时转换为相应的合并公司证券。
合并后的公司拟申请将其股票和认股权证在OTCM或全国性证券交易所上市,股票代码分别为“[·]”和“[·]”。普通股在OTCM或国家证券交易所上市是收盘的条件。无法保证合并后的公司将能够满足初始上市要求或在业务合并完成后继续上市的要求。
持有人
截至记录日期营业结束时,ACIC普通股有5,814,703股未发行,ACIC单位记录持有人[·]、普通股记录持有人[·]和公开认股权证记录持有人[·]。记录持有人的数量不包括数量大得多的“街道名称”持有人或实益持有人,其ACIC单位、普通股和公开认股权证由银行、经纪商和其他金融机构记录在案。
股息政策
到目前为止,ACIC尚未就其普通股支付任何现金股息,也不打算在企业合并完成之前支付任何现金股息。未来现金红利的支付将取决于合并后公司的收入和收益(如果有的话)、资本需求和业务合并完成后的一般财务状况。合并后的任何现金股息的支付将由合并后的公司董事会在此时酌情决定。
GIO
GIO的任何股票都没有公开市场。
52
风险因素
在决定是否或如何投票或指示投票批准本代理声明/招股说明书中所述的提案之前,您应仔细考虑以下所有风险因素,以及本代理声明/招股说明书中包含或以引用方式纳入的所有其他信息,包括财务信息。
在完成业务合并后,贵方的投资价值将受到重大风险的影响,除其他外,影响合并后公司的预期业务、财务状况或经营业绩。如果发生下述任何事件,合并后公司的业务合并后业务和财务结果可能在重大方面受到不利影响。这可能会导致合并后公司证券的交易价格大幅下跌,因此你可能会损失全部或部分投资。下面描述的风险因素不一定是详尽无遗的,我们鼓励您对ACIC和GIO的业务进行自己的调查。下列某些风险因素适用于GIO的业务和业务,也适用于合并后公司在业务合并完成后的业务和业务。这些风险因素中所述的一个或多个事件或情况的发生,单独或与其他事件或情况一起发生,可能会对完成或实现业务合并的预期效益的能力产生不利影响,或可能对合并后公司的业务、财务状况、经营业绩、前景和交易价格产生重大不利影响。下文讨论的风险可能不是详尽无遗的,而是基于ACIC和GIO所作的某些假设,这些假设后来可能被证明是不正确或不完整的。合并后的公司、ACIC和GIO可能面临其他风险和不确定因素,这些风险和不确定因素目前并不为他们所知,或者目前被认为无关紧要,但最终也可能对任何此类当事方产生不利影响。以下讨论应与题为“关于前瞻性陈述的注意事项”、“管理层对GIO财务状况和经营成果的讨论和分析”和“管理层对ACIC财务状况和经营成果的讨论和分析”的章节以及GIO和ACIC的财务报表及其附注一并阅读。
与业务合并有关的风险
ACIC股东行使公众股份赎回权的能力或其他因素可能不允许ACIC完成业务合并或优化其资本结构。
如果NTA提案未得到ACIC股东的批准并由ACIC实施,并且提交赎回的公众股份数量超过ACIC目前的预期,并且此类赎回或其他条件被确定为无法满足ACIC当前章程中规定的有形资产净值要求,ACIC可能需要寻求重组交易,以在信托账户中保留更大比例的现金,或安排第三方融资(或额外的第三方融资,如适用)。ACIC可能无法以优惠条件或根本无法获得第三方融资。此外,筹集更多的第三方融资可能涉及稀释性的股票发行或产生高于适当水平的债务。此外,如果NTA提案未得到ACIC股东的批准并由ACIC实施,则ACIC在企业合并中的交割条件是,在赎回付款和任何交易融资之后,ACIC在交割时拥有至少5000,001美元的现金或现金等价物,由于已赎回的公众股份数量或缺乏可用的第三方融资(或两者皆有),因此可能无法满足,并且拟议的企业合并可能无法完成。
如果业务合并不成功,在ACIC清算信托账户或完成替代的初始业务合并之前,或在发生《现行章程》规定的延期或某些其他公司行动之前,您将不会收到您按比例支付的信托账户部分。如果您需要即时流动资金,您可以尝试在OTCM上出售您的ACIC普通股;但是,在此期间,ACIC普通股的交易价格可能低于信托账户中按比例计算的每股金额,或者在此期间市场需求可能有限。在任何一种情况下,你的投资都可能遭受重大损失,或失去与ACIC赎回有关的预期资金收益,直到ACIC清算、完成另一种初始业务合并、实施延期或采取现行章程中规定的某些其他行动,或者你能够在公开市场上出售你的股票。
你可能无法确定GIO运营的好处或风险。
如果业务合并得以完成,合并后的公司将受到合并后公司预期从事的业务中固有的许多风险的影响。尽管ACIC的管理层一直在努力评估拟议中的与GIO的业务合并的内在风险,但ACIC无法向您保证,它能够充分确定或评估所有重大风险因素,其中许多因素可能无法预见,也可能不在ACIC或GIO的控制范围内。ACIC也
53
如果有机会的话,投资ACIC的证券最终不会比直接投资GIO对ACIC的投资者更有利。此外,如果ACIC的股东认为企业合并的前景不乐观,更多的股东可能会行使其赎回权,这可能会使ACIC难以完成企业合并。
无法保证ACIC的尽职调查将揭示目前或未来可能与GIO相关的所有重大风险;此外,随着GIO继续推进其预期的业务线,它将遇到无法预测且可能不在GIO控制范围内的风险,这些风险可能是重大的,并对GIO产生不利影响。在业务合并完成后,合并后的公司可能被要求进行减记或注销、重组和减值或其他费用,这些费用可能对其财务状况和股价产生重大负面影响,从而可能导致你损失部分或全部投资。
ACIC无法向您保证,ACIC对GIO进行的尽职调查将揭示所有可能与GIO相关的重大问题;此外,鉴于GIO处于开发前阶段,不可能通过惯常的尽职调查发现所有重大问题,也不可能在以后不会出现ACIC控制之外的风险。GIO知道,ACIC必须在2023年8月14日之前完成初步业务合并(除非ACIC的股东延长了这一日期)。因此,GIO可能已经获得了对ACIC的控制权,因为它知道,如果ACIC没有完成业务合并,ACIC可能不太可能在截止日期之前完成与任何其他目标业务的初始业务合并。此外,ACIC开展尽职调查的时间有限。因此,ACIC在有限的信息基础上决定与GIO进行业务合并,这可能导致业务合并的利润不如预期,甚至根本没有。由于这些因素,合并后的公司可能被迫在以后减记或注销资产,重组业务,或产生可能导致报告损失的减值或其他费用。
即使ACIC的尽职调查成功地发现了某些风险,也可能会出现意想不到的风险(对于尚未实施业务计划的GIO,很可能会出现),并且以前已知的风险可能会以与我们的初步风险分析不一致的方式发生。尽管这些费用可能是非现金项目,不会立即对ACIC的流动性产生影响,但ACIC报告这种性质的费用,可能会加剧市场对ACIC或ACIC证券的负面看法。此外,这种性质的指控可能导致ACIC违反其可能因承担GIO持有的先前存在的债务或因其在交割后获得债务融资而受到约束的杠杆或其他契约。因此,ACIC的任何股东如果在企业合并后选择继续作为合并后公司的股东,其股票价值可能会减少。除非这些股东能够成功地声称,减持是由于ACIC的高管或董事违反了他们对ACIC负有的注意义务或其他受托责任,或者他们能够成功地根据证券法私下声称,本代理声明/招股说明书所包含的登记声明包含可起诉的重大错误陈述或重大遗漏,否则这些股东不太可能对此类价值减少获得补救。
尽管ACIC董事会获得并认为其独立财务顾问提供的公平意见是ACIC董事会对拟议业务合并进行评估时考虑的若干因素之一,但向公平意见提供者和ACIC提供的关于GIO的信息本质上是说明性的,并非基于实际或历史信息,并且受到各种已知和未知的假设、风险和意外情况的影响,特别是考虑到GIO尚未开始业务运营或尚未制定执行其预期业务线的计划。因此,ACIC董事会可能没有对GIO进行正确估值,也无法保证ACIC为GIO支付的价格从财务角度来看对ACIC及其股东是公平的。
正如本代理声明/招股说明书的其他部分所述,ACIC董事会在其关于拟议与GIO的业务合并的决策过程中考虑了一些积极和消极的因素,其中之一是全球咨询和交易公司EverEdge向ACIC董事会提供的关于拟议业务合并(包括根据该合并可向GIO卖方发行的交易所对价)从财务角度对ACIC股东的公平性的意见。EverEdge专注于商业估值实践和无形资产,被ACIC选为ACIC的财务顾问,目的是根据EverEdge的经验和及时完成任务的能力提供意见。ACIC就公平意见向EverEdge支付的服务费是在执行与EverEdge为此目的而进行的业务相关的信函协议时以及在提交公平意见时支付给EverEdge的,而不取决于EverEdge意见中所表达的结论或业务合并的完成。EverEdge在编写其意见时假定并依赖GIO管理层提供给EverEdge的某些财务信息和其他信息的准确性和完整性,以及用于EverEdge分析目的的关于上市公司准则的公开信息;提供给或以其他方式提供给EverEdge的所有信息,
54
与EverEdge讨论过或由EverEdge审查过,但EverEdge在没有对此类信息进行任何独立核实的情况下依赖这些信息(EverEdge对此类信息的任何独立核实不承担任何责任或义务)。EverEdge向EverEdge提供和利用的与其审查拟议业务合并有关的分析资料包括某些GIO管理层的预测,这些预测纯粹是说明性的,完全涉及GIO迄今尚未确立或开展的业务领域和业务活动,其中包括与GIO及其潜在的未来业务活动可能产生的潜在未来价值有关的各种假设,这些假设或这些假设所依据的信息都不是基于或与GIO的任何当前或历史事实或信息相关联的,GIO尚未开始业务运营。这些假设和提供给EverEdge的GIO管理层预测,如本代理声明/招股说明书中“业务合并的背景”标题下的业务合并建议中的一节所进一步描述的,本质上是说明性的,并受到已知和未知的众多风险和意外事件的影响,其中许多风险和意外事件不在ACIC或GIO的控制之下,无法提前预测,特别是因为GIO尚未开始业务运营。由于GIO作为一家企业所处的发展阶段,尽管ACIC董事会收到了这些GIO管理层预测的副本,但ACIC董事会决定不将这些信息作为ACIC董事会对拟议业务合并的评估的一部分,而是将ACIC管理层编写并提交给ACIC董事会的某些财务分析作为ACIC董事会决策过程的一部分,这也在这份委托书/招股说明书中题为“业务合并的背景”的部分进一步描述。提供给EverEdge的GIO管理层预测不是GIO在正常过程中保持的详细财务预测。此外,这些GIO管理层预测中所包含的所有信息和假设都是说明性的,可能会有多种解释,完全取决于关于一项业务和业务线的许多假设,这些假设尚不存在,以及可能会或可能不会发生的各种事件和情况,它们无意构成也不应被解释为代表对GIO未来业务或其前景的预测、预测或估计,它们与关于GIO的实际或历史信息无关。
ACIC董事会审查并分析了公平性意见提供者向ACIC董事会描述的公平性意见和EverEdge分析,并考虑了一些因素、不确定性和风险,包括但不限于在“业务合并提案—— ACIC董事会的建议和业务合并的原因”下讨论的因素,以决定继续与GIO进行拟议的业务合并。行政协调会理事会还审查了“业务合并的背景”一节中所述的行政协调会管理层财务分析以及作为其决策过程一部分的尽职调查结果。然而,尽管做出了这些努力,但无法保证ACIC的董事会以及由ACIC或代表ACIC进行的尽职调查和分析揭示了GIO可能存在的所有重大风险。此外,鉴于GIO尚未开始业务活动,而且在进行拟议的业务活动时,可能会遇到不可预见的风险和挑战,并可能不时和随着时间的推移改变其计划,因此估计GIO的潜在未来价值尤其具有挑战性。此外,ACIC对GIO的估值本身高度依赖于本委托书/招股说明书中列出的风险因素,以及其业务计划的可实现性和这些计划的可行性等因素,所有这些因素都具有相当大的不确定性。因此,如果GIO的实际业务线及其结果与GIO向ACIC提供的、ACIC及其顾问在ACIC董事会尽职调查中所依赖的信息以及公允意见的部分估值所依据的信息存在重大差异,合并后公司的业绩和盈利能力可能会受到重大不利影响。因此,投资者在对GIO进行估值时将完全依赖ACIC董事会的判断,而ACIC董事会可能没有可获得的信息,或者可能没有对这些企业进行适当估值。
ACIC董事会认为,由于其董事的专业经验和背景,它有资格得出这样的结论:从财务角度来看,业务合并对其股东是公平的,GIO的公平市场价值至少是信托账户价值的80%(不包括信托账户持有的递延承销折扣和就信托账户赚取的收入应缴纳的税款)。因此,投资者在对GIO进行估值时将完全依赖ACIC董事会的判断,而ACIC董事会可能没有对这些企业进行适当的估值。因此,从财务角度来看,这些条款可能对ACIC的公众股东不公平。依赖ACIC管理层分析的说明性以及GIO尚未就其拟议的业务线开始运营的事实,也可能导致越来越多的ACIC股东投票反对业务合并或要求赎回他们所持的ACIC股份,这可能会影响ACIC完成业务合并的能力。有关ACIC董事会在评估业务合并协议和拟议的与GIO的业务合并时使用的标准的信息,请参见标题“业务合并提议—— ACIC管理层财务分析”下的进一步说明。
55
对于非保荐人关联公司的ACIC股东而言,存在通过业务合并而不是通过承销公开发行直接购买GIO证券而成为合并后公司股东的风险,包括承销商不进行独立的尽职审查。
由于没有独立的第三方承销商参与企业合并或与之相关的ACIC证券的发行,投资者将不会受益于对ACIC和GIO各自财务和运营的任何外部独立审查。持牌经纪-交易商承销的公开发行证券须经承销商或交易商经理进行尽职审查,以履行《证券法》、金融业监管局(FINRA)规则和此类证券上市地国家证券交易所规定的法定职责。此外,进行此种公开发行的承销商或交易商-经理人须对与公开发行有关的登记声明中的任何重大错误陈述或遗漏承担赔偿责任。由于不会就企业合并进行此类审查,ACIC股东必须依赖本代理声明/招股说明书中的信息,因此不会受益于独立承销商在公开证券发行中通常进行的那种类型的独立审查和调查。
如果GIO通过承销公开发行成为一家上市公司,承销商将根据《证券法》第11条对首次公开发行登记声明中的重大错误陈述和遗漏承担责任。一般来说,如果承销商能够证明,它“在经过合理调查后,有合理理由相信并在……登记声明生效时确实相信其中的陈述(经审计的财务报表除外)是真实的,并且没有遗漏陈述必须在其中陈述或使其中的陈述不具有误导性所必需的重大事实”,那么它就能够避免承担第11条规定的赔偿责任。
为了履行其进行“合理调查”的职责,承销商除了自行进行大量的尽职调查外,通常还会要求发行人的独立注册会计师事务所就注册声明中包含的某些数字提供一份安慰函,并要求发行人的律师事务所在其提交给承销商的法律意见书中包含一份声明,说明该律师不知道首次公开发行注册声明中存在任何重大错误陈述或遗漏(“律师负面保证声明”)。对于通过与ACIC等特殊目的收购公司合并而上市的私营公司,一般不需要审计师安慰函和律师负面保证声明,也没有要求或获得与企业合并或编制本联合代理声明/同意征求声明/招股说明书有关的审计师安慰函或律师负面保证声明。
此外,ACIC及其顾问就业务合并所进行的尽职调查可能没有承销商就GIO首次公开发行所进行的尽职调查高。因此,如果GIO进行承销公开发行,GIO的业务缺陷或GIO管理层的问题可能不会被发现与业务合并有关,这可能会对合并后公司普通股的市场价格产生不利影响。
与承销的首次公开发行不同,合并后公司证券的首次交易将不会受益于承销商进行的簿记建档过程,该过程有助于为新上市股票的开盘交易提供有效的价格发现,以及承销商的支持,以帮助稳定、维持或影响新发行股票上市后的公开价格。由于缺乏与交易相关的这一程序,可能导致投资者需求减少,定价效率低下,合并后公司证券在交易结束后的一段时间内的公开价格更加不稳定。
在题为“未经审计的合并财务报表”的一节中,未经审计的预计财务资料可能不代表合并后公司的结果,如果业务合并已经完成,因此,你将只有有限的财务资料来评价合并后公司的财务业绩和你的投资决定。
ACIC和GIO目前分别作为独立公司运营。ACIC以前没有运营公司的历史,其业务以前也不是合并管理的。备考财务信息仅供参考,并不一定表明如果在所示日期或截至日期完成业务合并,本应实际发生的财务状况或业务结果,也不一定表明合并后公司未来的业务结果或财务状况。预计的业务报表不反映业务合并产生的未来非经常性费用。未经审计的预计财务信息没有反映业务合并后可能发生的未来事件,也没有考虑当前市场状况对收入或支出的潜在影响。形式
56
题为“未经审计的备考简明合并财务报表”一节中的财务信息来自ACIC和GIO的历史财务报表,并在业务合并生效后对合并后公司进行了某些调整和假设。预计财务资料中的初步估计数与最后购置会计之间将出现差异,并可能对预计财务资料和合并后公司的财务状况及未来业务结果产生不利影响。
此外,在编制预计财务资料时使用的假设可能不准确,其他因素可能影响合并后公司的财务状况或关闭后的业务结果。合并后公司的财务状况或经营业绩的任何潜在下降都可能导致合并后公司的股价发生重大变化。
ACIC依赖于其执行官员和董事,他们的离职可能会对ACIC的运营和完成初始业务合并的能力产生不利影响。此外,ACIC的高管和董事还会将时间分配给其他业务,从而引发潜在的利益冲突,这可能会对ACIC完成初始业务合并的能力产生负面影响。
ACIC的运营及其完成业务合并的能力取决于相对较小的个人群体,尤其是其执行官和董事。ACIC认为,其成功取决于其执行官员和董事的持续服务,至少在业务合并完成之前是如此。ACIC没有与其任何董事或执行官签订雇佣协议,也没有为其提供终身保险。ACIC的一名或多名董事或执行官意外失去服务,可能会对ACIC和完成业务合并的能力产生不利影响。此外,ACIC的执行干事和董事无需为其事务投入任何规定的时间,因此,在为各种业务活动分配管理时间,包括监督尽职调查和采取完成业务合并所需的其他行动方面,将存在利益冲突。ACIC的每一位高管都从事其他几项业务,他们可能有权获得丰厚的报酬,ACIC的董事还担任其他实体的高管和董事会成员。如果ACIC的执行官员和董事的其他业务要求他们在这些事务上投入大量时间,超过他们目前的承诺水平,这可能会限制他们在ACIC事务上投入时间的能力,这可能会对ACIC完成业务合并的能力产生负面影响。
合并后公司能否在业务合并后取得成功将取决于合并后公司董事会及其管理人员的努力,而这些人员的流失可能会对合并后公司业务合并后业务的运营和盈利能力产生负面影响。
合并后公司能否在业务合并后取得成功,将取决于合并后公司董事会及其管理人员,包括GIO首席科学官Anand Srivastava博士的努力。ACIC不能向你保证合并后公司的董事会及其管理人员将会有效或成功,或继续留在合并后的公司。除了他们将面临的其他挑战外,这些人可能不熟悉运营上市公司的要求,这可能导致合并后公司的管理层不得不花费时间和资源帮助他们熟悉这些要求。
据估计,根据业务合并协议,ACIC的公众股东将拥有合并后公司约5.1%的股权或资产(假设没有赎回),ACIC的管理层,除了预计将在合并后公司董事会任职的Joel Shulman博士以外,将不参与合并后公司未来业务的管理。
由于ACIC的内部人士将失去他们在ACIC的全部投资,如果企业合并或替代企业合并没有完成,并且由于ACIC的保荐人、执行官员和董事将没有资格获得补偿,如果企业合并没有完成,在确定GIO是否适合ACIC的初始企业合并时,可能会产生利益冲突。
ACIC的保荐人目前拥有ACIC的多项权益,截至2023年5月9日,这些权益的总价值约为822.5万美元,如果ACIC不完成业务合并,这些权益可能会一文不值。ACIC的保荐人目前拥有4,312,500股创始人股份,根据公众股份在2023年5月9日的收盘价计算,截至同日,这些股份的总价值约为4,530万美元。此外,保证人共购买了8200000份私人认股权证,这些认股权证的总价值约为328000美元,假定私人认股权证的每份认股权证价值与
57
2023年5月9日公开认股权证在OTCM的收盘价为0.04美元。此外,虽然ACIC的董事和高级职员与业务合并有关的自付费用(如果这些费用超过未存入信托账户的可用收益的数额)可由ACIC偿还,但截至2023年[·],ACIC的任何董事或高级职员都没有发生他们预期在结算时得到偿还的任何费用。
ACIC执行官员和董事的个人和财务利益可能影响了他们确定和选择目标企业合并、完成初始企业合并以及影响初始企业合并后企业运营的动机。在ACIC的初始业务合并结束时,其保荐人、执行官员和董事或他们各自的任何关联公司将(i)获得补偿,用于支付与代表ACIC开展的活动有关的任何自付费用,例如确定潜在的目标业务和对合适的业务合并进行尽职调查,以及(ii)收到根据行政支助协议支付的未付应计费用,金额为140000美元(截至2022年12月31日)。
如果企业合并或另一种企业合并已经完成,代表ACIC开展的活动所产生的自付费用的偿还不设上限或上限。然而,如果企业合并或替代企业合并未完成,ACIC的保荐人、执行官员和董事或他们各自的任何关联公司将没有资格获得任何此类补偿。如果企业合并或替代企业合并未完成,ACIC可能无法根据行政支助协议向保荐人支付未支付的应计费用。
ACIC的保荐人、执行人员和董事的这种财务利益可能影响了他们批准企业合并的动机,并可能影响他们完成企业合并的动机。见题为“建议1:企业合并建议—— ACIC董事和高级管理人员及其他人员在企业合并中的权益”和“证券的实益所有权”的章节。
ACIC的一些管理人员和董事可能会被认为存在利益冲突,可能会影响他们支持或批准业务合并,而不考虑你们的利益。
ACIC的某些高级职员和董事参与安排,为他们提供与你们不同的企业合并权益,包括(其中包括)继续担任合并后公司的高级职员或董事、遣散费、股权赠款、持续补偿以及可能出售合并后公司普通股更多股份的能力。如果企业合并未完成,ACIC被迫按照现行章程进行清盘、解散和清算,保荐人目前持有的4312500股创始人股份将一文不值(因为持有人已放弃对这些股份的清算权),这些股份最初是在IPO之前以25000美元的总收购价获得的。根据2023年[·]在场外交易市场上每股[·]美元的最后出售价格计算,方正股票的总市值约为[·]美元。因此,保荐人和ACIC的现任执行官和董事的利益可能与你作为股东的利益不同,或者除了你作为股东的利益之外。
除其他外,这些利益可能会影响ACIC的管理人员和董事支持或批准业务合并。有关ACIC执行官员和董事利益的更多信息,请参阅本委托书/招股说明书中题为“提案1:企业合并提案—— ACIC董事和高级管理人员在企业合并中的利益”的章节。
ACIC的保荐人控制着ACIC的大量权益,可以在没有其他股东投票的情况下批准企业合并和其他提案。
在与2022年12月21日ACIC股东大会有关的公众股东赎回后,保荐人拥有约74.2%的ACIC普通股流通股,有权在特别会议上投票。根据内幕信息交易协议的条款,保荐人已同意将其拥有的所有ACIC股票投票支持企业合并和其他提案。根据《现行章程》所载的条款和规定,假定特别会议达到法定人数,并且保荐人按照《内幕交易协议》的要求在特别会议上投票表决其股份,即使ACIC的部分或全部公众股东不批准业务合并或其他提案,企业合并和其他提案也可以在特别会议上获得批准
58
企业合并完成后,创始人股份的价值很可能大大高于为其支付的名义价格,即使当时合并公司普通股的交易价格大大低于每股10.00美元。
保荐人对ACIC的投资总额为8225000美元,其中包括创始人股份的25000美元购买价和私人认股权证的8200000美元购买价。假设合并完成后的交易价格为每股10.00美元,4312500股创始人股票的隐含总价值为43125000美元。即使合并后公司普通股的交易价格低至每股约1.90美元,而配售认股权证毫无价值,创始人股份的价值也将与保荐人对ACIC的初始投资相等。因此,即使公众股份损失了很大的价值,保荐人很可能能够收回其投资并从该投资中获得可观的利润。因此,在保荐人中拥有权益的ACIC管理团队可能具有不同于公众股东的经济激励,以追求和完成企业合并,而不是清算并将信托中的所有现金返还给公众股东。出于上述原因,在评估是否在业务合并之前或与业务合并相关时赎回股票时,您应该考虑ACIC管理团队完成业务合并的财务激励。
ACIC股东和GIO卖方可能无法从业务合并中获得与其在业务合并中将经历的所有权稀释相称的收益。
如果合并后的公司不能实现目前预期的业务合并带来的好处,ACIC股东和GIO卖方在各自公司中的所有权权益将被大幅稀释,而不能获得任何相应的好处,或仅获得部分相应的好处,但合并后的公司只能实现目前预期的业务合并带来的部分战略和财务好处。
在企业合并待决期间,由于《企业合并协议》的限制,ACIC和GIO可能无法与另一方进行企业合并,这可能对其各自的业务产生不利影响。此外,《企业合并协议》的某些条款可能会阻止第三方提出替代收购建议,包括可能优于《企业合并协议》所设想的安排的建议。
企业合并协议中的盟约妨碍了ACIC和GIO在企业合并完成之前进行收购或完成不在正常业务过程中的其他交易的能力。因此,如果没有完成业务合并,在此期间,双方可能会处于其竞争对手的不利地位。此外,在《企业合并协议》生效期间,一般禁止每一方当事人招揽、发起、鼓励或与任何第三方进行某些特殊交易,例如在正常经营过程之外的合并、资产出售或其他企业合并。任何此类交易都可能对此类交易方的证券持有人有利。
业务合并的完成取决于多项条件的满足,包括ACIC和GIO无法控制的某些条件。因此,关闭业务组合的一个或多个条件可能无法满足,并且业务组合可能无法完成。
即使企业合并得到ACIC股东的批准,也必须满足或放弃特定条件才能完成企业合并。这些条件在《企业合并协议》中有详细说明,除股东同意外,还包括:(一)收到必要的监管批准,没有阻止交易的法律或命令;(二)没有任何未决诉讼要求或限制交易结束;(三)每一方的陈述和保证在《企业合并协议》签订之日和交易结束时是真实和正确的(但须有重大不利影响);(四)每一方在所有重大方面遵守其盟约和协议,(v)满足上市规定,并批准有关股份在国家交易所的上市申请,(vi)自业务合并协议仍持续和未得到修正之日起,对任何一方没有重大不利影响,(vii)正在选举或任命的交割后董事会成员,以及(viii)一份有效的登记声明。更完整的摘要见下文“提案1:业务合并提案——业务合并协议——完成业务合并的条件”。ACIC和GIO不能向你保证所有的条件都会得到满足。如果条件未得到满足或放弃,则业务合并可能不会发生,或可能被延迟,而这种延迟可能导致ACIC和GIO各自丧失业务合并的部分或全部预期收益。如果业务合并没有发生,ACIC可能无法在ACIC的最后期限(目前为2023年8月14日)之前为其初始业务合并找到其他潜在候选人,ACIC将被要求进行清算。
59
特拉华州法律以及拟议章程和拟议章程将包含某些条款,包括反收购条款,这些条款限制股东采取某些行动的能力,并可能延迟或阻止股东可能认为有利的收购企图。
拟议章程和拟议章程将在企业合并完成后生效,以及DGCL包含的条款可能会增加合并后公司董事会认为不可取的收购的难度、延迟或阻止,从而压低合并后公司普通股的交易价格。这些规定还可能使股东难以采取某些行动,包括选举不是由GIO董事会现任成员提名的董事,或采取其他公司行动,包括对合并后公司的管理层进行改革。除其他事项外,拟议章程和拟议附例包括以下方面的规定:
| ● | 合并后的公司董事会有能力发行优先股,包括“空白支票”优先股,并在未经股东批准的情况下确定这些股份的价格和其他条款,包括优先权和投票权,这可被用于大幅稀释敌意收购者的所有权; |
| ● | 合并后公司的董事和高级职员的责任限制和赔偿; |
| ● | 合并后的公司董事会有权选举一名董事,以填补因合并后的公司董事会扩大或一名董事辞职、死亡或被免职而产生的空缺,从而使股东无法填补合并后公司董事会的空缺; |
| ● | 规定股东特别会议只可由(i)当时在任的董事召开;或(ii)合并后公司的秘书在收到一份或多于一份书面要求股东召开特别会议的书面要求后,合并后公司有权就拟提交特别会议的事项或事项投票的已发行股份的至少25%的投票权,而该等投票权须符合建议附例所载的召开股东特别会议的程序,可能会延迟股东强制考虑某项建议或采取行动(包括罢免董事)的能力; |
| ● | 控制董事会和股东大会的举行和安排的程序; |
| ● | 修改、更改、更改或废除《拟议章程》的某些条款,要求拥有当时所有已发行的有表决权股份的至少2/3表决权的持有人(作为一个单一类别共同投票)投赞成票,这可能会阻止股东将事项提交年度股东大会或股东特别会议,并延迟合并后公司董事会的变更,还可能会阻碍收购方进行此类修改以便利非邀约收购企图的能力; |
| ● | 合并公司董事会修订附例的能力,该等能力可容许合并公司董事会采取额外行动,以防止非邀约收购,并限制收购方修订附例以便利非邀约收购企图的能力;及 |
| ● | 股东在提名合并后公司董事会候选人或提议在股东大会上采取行动的事项时,必须遵守预先通知程序,这可能会阻止股东将事项提交年度股东大会或特别股东大会,并推迟合并后公司董事会的变动,还可能阻止或阻止潜在收购方进行代理人征集,以选举收购方自己的董事名单,或以其他方式试图获得合并后公司的控制权。 |
这些规定,无论是单独还是一起,都可能延迟或阻止敌意收购和控制权变更或合并后公司董事会或管理层的变更。
拟议章程、拟议章程或特拉华州法律中任何具有延迟或阻止控制权变更效力的条款,都可能限制股东获得合并后公司普通股股份溢价的机会,也可能影响某些投资者愿意为合并后公司普通股股份支付的价格。
60
拟议章程将指定设在特拉华州的一个州或联邦法院作为合并后公司与其股东之间几乎所有纠纷的专属法院,并规定联邦地区法院将是解决根据《证券法》提出诉讼理由的任何投诉的专属法院,每一项诉讼理由都可能限制合并后公司股东就与合并后公司或其董事、高级职员或雇员之间的纠纷选择司法法院的能力。
拟议章程将于交易结束时生效,该章程将规定,除非合并公司书面同意选择另一诉讼地,否则,(i)代表合并公司提起的任何派生诉讼或法律程序,(ii)声称其董事、高级人员或合并公司的其他雇员或其股东所负的信托责任遭到违反的诉讼,(iii)依据DGCL的任何规定而提起的任何诉讼的唯一和排他性诉讼地,或成立为法团的证明书或附例,或(iv)主张受内部事务原则管辖的申索的任何其他诉讼,均须由特拉华州衡平法院负责,但任何诉讼(A)除外,而特拉华州衡平法院裁定有一不可缺少的一方不受衡平法院的管辖(而该不可缺少的一方在裁定后十天内不同意衡平法院的属人管辖权),(B)属衡平法院以外的法院或法院的专属司法管辖权的,或(C)属衡平法院不具有标的司法管辖权的。拟议宪章还将规定,美利坚合众国联邦地区法院将是解决根据《证券法》提出诉讼理由的任何申诉的唯一论坛。除某些例外情况外,专属法院地条款将在适用法律允许的最大限度内适用。《交易法》第27节对为执行《交易法》或其下的规则和条例所产生的任何义务或责任而提起的所有诉讼规定了专属的联邦管辖权。因此,专属法院地条款将不适用于为执行《交易法》规定的任何义务或赔偿责任而提起的诉讼,也不适用于联邦法院拥有专属管辖权的任何其他索赔。然而,我们注意到,法院是否会执行这一规定存在不确定性,投资者不能放弃遵守联邦证券法律及其规定的规则和条例。《证券法》第22条规定,州法院和联邦法院对为执行《证券法》或相关规则和条例规定的任何义务或责任而提起的所有诉讼同时拥有管辖权。
任何人或实体购买或以其他方式获得合并后公司任何证券的任何权益,应视为已通知并同意本规定。这一法院选择条款可能会限制股东在其认为有利于与我们或我们的董事、高级职员或其他雇员发生纠纷的司法法院提出索赔的能力,或者可能导致股东提出索赔的成本增加,特别是如果他们不住在特拉华州或附近,这两种情况都可能阻止针对我们和我们的董事、高级职员和雇员的此类诉讼。或者,如果法院裁定这些规定不适用于一种或多种特定类型的诉讼或程序,或对此种诉讼或程序不可执行,合并公司可能会因在其他法域解决此类事项而产生额外费用,这可能会对合并公司的预期业务和财务状况产生不利影响。
保荐人、董事、高级管理人员及其关联机构可以选择向ACIC公众股东购买公众股份或公开认股权证,这可能会影响对拟议的首次企业合并的投票,并减少公众股份的“流通股”。
在特别会议之前的任何时间,在他们不知道有关ACIC或ACIC证券的任何重大非公开信息的时期内,ACIC的保荐人、GIO或他们各自的关联公司可以从投资者那里购买公众股份或认股权证,或者他们可以与这些投资者和其他人进行交易,为他们提供激励,以购买公众股份或投票支持企业合并提案,或撤回任何赎回请求。在这种交易中,购买公众股份的价格将不超过赎回价格。此外,根据内幕信息交易协议的条款,上述人士将放弃对其在此类交易中获得的公众股份的赎回权(如果有的话)。然而,上述人士取得的任何公众股份将不会就企业合并建议进行表决。
这种股份购买和其他交易的目的是增加完成业务合并的条件得到满足的可能性。这可能会导致我们的业务合并的完成,而这本来是不可能的。尽管截至本代理声明/招股说明书发布之日,任何此类激励措施的确切性质尚未确定,但它们可能包括但不限于保护此类投资者或持有人免受其股票价值潜在损失的安排,包括授予看跌期权。
订立任何该等奖励安排,可能对公众股份有抑制作用。例如,由于这些安排,投资者或持有者可能有能力以低于市场的价格有效购买股票,因此可能更有可能在特别会议之前或之后出售该投资者或持有者拥有的股票。
61
截至本代理声明/招股说明书之日,尚未进行过此类讨论,也未与任何此类投资者或持有人达成任何此类协议。如果订立此类安排或协议,ACIC将在特别会议之前提交一份8-K表格的当前报告,以披露上述任何人订立的任何安排或进行的重大采购。任何此类报告将包括(i)购买的公众股份的数量和购买价格;(ii)购买的目的;(iii)此类购买对企业合并交易获得批准的可能性的影响;(iv)如果不是在公开市场购买,则出售股份的证券持有人的身份或特征或卖方的性质;以及(v)ACIC收到赎回请求的公众股份的数量。
此外,如果进行此类购买,公众股份或公开认股权证的公开“流通股”以及我们证券的实益持有人数量可能会减少,这可能会使我们难以获得或维持ACIC证券在国家证券交易所的报价、上市或交易。
赎回其公开股份的ACIC股东可继续持有其所拥有的任何公开认股权证,这将导致在行使此类公开认股权证时对未赎回的ACIC股东造成稀释。
赎回其公众股份的ACIC股东可继续持有他们在此期间拥有的任何公开认股权证,这将导致在行使此类认股权证时对非赎回持有人的额外稀释。假设(a)在ACIC首次公开发行中获得ACIC单位的所有可赎回ACIC股东并继续持有此类ACIC单位中包含的公开认股权证,以及(b)可赎回ACIC股东持有的公开股票的最大赎回,则可通过赎回ACIC股东保留8,625,000份公开认股权证。因此,截至2023年[·],赎回的ACIC股东将持有总市值约为[·]美元的公开认股权证,而非赎回的ACIC股东在行使赎回的ACIC股东持有的公开认股权证时,其在合并后公司的所有权百分比和投票权将受到稀释。
公众股东行使公众股份赎回权的能力可能妨碍ACIC完成业务合并或使其资本结构最大化。
ACIC不知道有多少公众股东将最终行使与企业合并有关的赎回权。因此,企业合并的结构是基于ACIC(以及《企业合并协议》其他各方)对任何公开股票赎回生效后信托账户可用资金数额的预期。
影响金融服务业的不利事态发展,包括涉及流动性、违约或金融机构不履约的事件或担忧,可能对ACIC的业务、财务状况或经营业绩或ACIC的前景产生不利影响。
ACIC运营账户和信托账户中的资金存放在银行或其他金融机构。ACIC在无息和计息账户中持有的现金将超过任何适用的联邦存款保险公司(FDIC)保险限额。如果发生的事件,包括流动性有限、违约、不履约或其他不利发展,涉及持有我们资金的银行或其他金融机构,或影响金融机构或整个金融服务行业,或对任何此类事件或其他类似风险的担忧或谣言,ACIC的流动性可能会受到不利影响。例如,2023年3月10日,美国联邦存款保险公司宣布,硅谷银行(简称“硅谷银行”)已被加州金融保护和创新部关闭。尽管ACIC在硅谷银行或其他已关闭的机构中没有任何资金,但ACIC不能保证持有其资金的银行或其他金融机构不会遇到类似问题。同样,在2023年3月12日,Signature银行和Silvergate资本公司也分别进入破产管理程序。尽管SVB的储户可以使用他们的资金,但更广泛的金融服务行业的不确定性和流动性担忧仍然存在。通货膨胀和利率的迅速上升导致以前发行的利率低于当前市场利率的政府证券的交易价值下降。美国财政部、联邦存款保险公司和联邦储备委员会宣布了一项计划,向金融机构提供高达250亿美元的贷款,这些贷款由金融机构持有的政府证券担保,以降低出售此类证券可能造成损失的风险。然而,对客户提款的广泛需求或金融机构对即时流动性的其他需求可能超出这种方案的能力。不能保证美国财政部、联邦存款保险公司和联邦储备委员会将来在其他银行或金融机构及时关闭或完全关闭的情况下提供未投保资金。
此外,投资者对美国或国际金融体系的担忧可能会导致不那么有利的商业融资条件,包括更高的利率或成本、更严格的金融和经营契约,或对准入的系统性限制
62
信贷和流动性来源,从而使我们更难以对ACIC有利的条件获得与潜在业务合并相关的融资,或根本无法获得融资,并可能对ACIC的流动性、业务、财务状况或经营业绩及其前景产生重大不利影响。ACIC的业务可能会受到这些事态发展的不利影响,其方式目前无法预测,还可能存在ACIC尚未发现的其他风险,而且ACIC不能保证它能够直接或间接地避免一家或多家银行或其他金融机构破产造成的负面后果。
GIO将需要额外的融资来为其运营或增长提供资金。如果ACIC或GIO无法获得额外融资,它们可能被迫重组或放弃业务合并。
GIO需要额外的融资来为其运营和增长提供资金。业务合并旨在成为GIO的一个融资来源,ACIC和GIO打算就业务合并的完成签订一项或多项融资协议。我们不能向你保证,这种融资将以可接受的条件提供,如果有的话。未能获得额外融资可能会对GIO业务的持续发展或增长产生重大不利影响。ACIC或GIO各自的管理人员、董事或股东均无需在企业合并前后提供任何融资。此外,如果在需要时证明无法获得额外融资,ACIC和GIO可能被迫重组交易或放弃业务合并。如果ACIC无法完成业务合并,ACIC公众股东只能收到信托账户中可分配给ACIC公众股东的按比例部分的资金,公开认股权证将一文不值。
与企业合并有关的法律程序,其结果是不确定的,可能会延迟或阻止企业合并的完成。
证券集团诉讼和衍生诉讼通常是针对已订立企业合并或类似协议的公司和/或其高级职员和董事提起的,这些公司指控,除其他外,就此类企业合并提交的委托书/招股说明书包含虚假和误导性陈述和/或遗漏了有关企业合并的重要信息。即使这些诉讼毫无根据,为这些索赔进行辩护也可能造成巨大的费用,并占用管理人员的时间和资源。不利判决可能导致金钱损失,这可能对ACIC和GIO的流动性和财务状况产生负面影响。此外,如果原告成功获得禁止完成业务合并的禁令,那么该禁令可能会延迟或阻止业务合并的完成或在预期时间范围内完成,这可能会对ACIC和GIO各自的业务、财务状况和经营业绩产生不利影响。虽然尚未就企业合并提起此类诉讼,但可能会出现此类诉讼,如果确实出现此类诉讼,除其他外,这些诉讼一般会寻求强制性救济和判给律师费和开支。为这类诉讼辩护可能需要ACIC和/或GIO承担巨额费用,并将ACIC和GIO管理层的注意力从业务合并中转移开。此外,在企业合并完成时仍未解决的任何诉讼或索赔的辩护或解决可能会对合并后公司的预期业务、财务状况、经营业绩和现金流量产生不利影响。这类法律程序可能会延迟或阻止企业合并在商定的时限内生效。
业务合并以及业务合并的不确定性可能导致供应商或战略合作伙伴推迟或推迟有关GIO的决定,并对GIO有效管理各自业务的预期能力产生不利影响。
只有在满足所述条件,包括相关股东批准等条件的情况下,企业合并才会发生。许多条件不在ACIC和GIO的控制范围内,双方也有权终止业务合并协议。因此,业务合并的完成可能存在不确定性。这种不确定性可能导致供应商、潜在战略合作伙伴或其他与GIO进行交易或可能与GIO进行交易的人推迟或推迟与GIO签订合同或做出与GIO有关的其他决定,或可能导致此类客户、供应商、供应商、战略合作伙伴或其他人寻求改变或取消与GIO的现有业务关系(如果有的话),这可能对其各自的业务产生负面影响。这些决定的任何延迟或推迟或任何现有协议的变更都可能对GIO的业务产生不利影响,无论业务合并是否最终完成。
63
与合并后公司普通股所有权相关的风险
合并后公司证券的活跃市场可能不会发展,这将对合并后公司证券的流动性和价格产生不利影响。
合并后公司的证券价格可能因合并后公司的特定因素以及一般市场或经济条件而有很大差异。此外,合并后公司证券的活跃交易市场可能永远不会发展,如果发展起来,也可能无法维持。你可能无法出售你的证券,除非一个市场能够建立和持续。
合并后公司普通股的市场价格可能会因合并而下跌。
合并后的公司普通股的市场价格可能会因以下原因而下跌,原因包括:
| ● | 投资者对合并后公司的业务前景和业务合并的前景反应消极; |
| ● | 业务合并对合并后公司业务前景的影响与金融或行业分析师的预期不一致;或 |
| ● | 合并后的公司没有像金融或行业分析师预期的那样迅速或达到预期的程度,实现业务合并的好处。 |
合并后公司的股价可能会在合并后发生重大变化,你可能会因此损失全部或部分投资。
合并后公司普通股股票的交易价格可能会波动。股票市场最近经历了极端的波动。这种波动往往与特定公司的经营业绩无关或不成比例。您可能无法以有吸引力的价格转售您所持有的合并后公司普通股,原因包括“—与影响GIO的运营因素相关的风险”、“—与影响GIO的监管、法律和税务因素相关的风险”以及以下几个因素:
| ● | 不同于证券分析师和投资者预期的经营业绩; |
| ● | 与合并后公司的竞争对手不同的经营业绩; |
| ● | 对合并后公司未来财务业绩的预期变化,包括证券分析师和投资者的财务估计和投资建议; |
| ● | 股票市场价格普遍下跌; |
| ● | 合并后公司或其竞争对手的战略行动; |
| ● | 合并后公司或其竞争对手关于重大合同、收购、合资、其他战略关系或资本承诺的公告; |
| ● | 合并后公司管理层的任何重大变动; |
| ● | 合并后公司的行业或市场的一般经济或市场状况或趋势的变化; |
| ● | 业务或监管条件的变化,包括适用于合并后公司未来业务的新法律或法规或对现有法律或法规的新解释; |
| ● | 合并后公司普通股或其他证券的未来出售; |
64
| ● | 投资者对合并后公司普通股相对于其他投资选择的投资机会的看法; |
| ● | 公众对合并后公司或第三方发布的新闻稿或其他公告的回应,包括合并后公司向美国证券交易委员会提交的文件; |
| ● | 涉及合并后公司、合并后公司未来可能参与的行业或两者兼而有之的诉讼,或监管机构对合并后公司董事会、合并后公司未来业务或合并后公司竞争对手业务的调查; |
| ● | 合并后公司向公众提供的任何指引、本指引的任何变更或合并后公司未达到本指引的情况; |
| ● | 一个活跃的合并后公司普通股交易市场的发展和可持续性; |
| ● | 机构股东或维权股东的行为; |
| ● | 会计准则、政策、准则、解释或原则的变更;以及 |
| ● | 其他事件或因素,包括由流行病、自然灾害、战争、恐怖主义行为或对这些未来事件的反应引起的事件或因素。 |
这些广泛的市场和行业波动可能会对合并后公司普通股的市场价格产生不利影响,无论合并后公司的实际经营业绩如何。此外,如果合并后公司普通股的公众持股量和交易量较低,价格波动可能会更大。
过去,随着市场的波动,股东会提起证券集体诉讼。如果合并后的公司卷入证券诉讼,可能会产生巨大的成本,并转移资源和行政管理人员对合并后公司未来业务的注意力,而不管此类诉讼的结果如何。
由于目前没有计划在可预见的将来支付合并公司普通股的现金股息,除非你以高于你支付的价格出售你的合并公司普通股,否则你可能不会获得任何投资回报。
合并后的公司打算保留未来的收益(如果有的话),用于未来的运营、扩张和偿还债务,目前没有计划在可预见的未来支付任何现金股息。合并后公司普通股股份的宣布、金额和未来股息的支付将由合并后公司董事会全权酌情决定。合并公司董事会可考虑一般和经济状况、合并公司的财务状况和经营成果、合并公司的可用现金以及当前和预期的现金需求、资本要求、合同、法律、税收和监管限制、合并公司向其股东或其子公司向其支付股息的影响以及合并公司董事会认为相关的其他因素。因此,除非你以高于你所支付价格的价格出售你所持有的合并公司普通股,否则你可能无法从合并公司普通股的投资中获得任何回报。
合并后的公司可能会增发合并后公司的普通股或其他股本证券,这会稀释你的所有权权益,并可能压低合并后公司普通股的市场价格。
合并完成后,合并后的公司将有认股权证尚未发行,可购买合并后公司的普通股共计16,825,000股。假设盈利目标得到满足,合并后的公司将需要向目前的GIO卖方额外发行至多5400万股合并后公司的普通股。此外,合并后的公司预计将寻求第三方融资,以提供额外的营运资金,以开展合并后公司的潜在业务,在这种情况下,合并后的公司可能会发行额外的股本证券。在企业合并完成后,合并后的公司还可出于任何原因或与收购、资本市场交易或其他事项有关的原因,在未来发行合并后公司的普通股或其他同等或更高级别的股本证券,包括但不限于合并后公司可能授予其董事、高级职员和雇员的股权奖励,或行使合并后公司的认股权证。
65
增发合并后公司的普通股或其他同等或更高级别的股本证券将产生以下影响:
| ● | 合并后公司的现有股东在合并后公司的股权比例将下降; |
| ● | 每股可动用的现金数额,包括用于支付未来股息的现金数额,可能会减少; |
| ● | 合并后的公司普通股的每一股以前发行在外的股票的相对投票权可能会被削弱;以及 |
| ● | 合并后的公司普通股的市场价格可能会下降。 |
如果证券或行业分析师不发表有关合并后公司未来业务的研究或报告,如果他们改变对合并后公司普通股股票的建议,或者如果合并后公司的未来经营业绩不符合他们的预期,合并后公司普通股股票的价格和交易量可能会下降。
合并后公司普通股股票的交易市场将部分取决于证券或行业分析师发布的有关合并后公司或其业务的研究和报告。如果没有证券或行业分析师开始报道合并后的公司,合并后公司普通股的交易价格可能会受到负面影响。如果证券或行业分析师开始报道,如果一名或多名报道合并后公司的分析师下调其证券评级或发表对其业务不利的研究,或者如果合并后公司的未来经营业绩不符合分析师的预期,合并后公司普通股的交易价格可能会下降。如果其中一名或多名分析师停止对合并后公司的报道或未能定期发布关于合并后公司的报告,对合并后公司普通股股票的需求可能会减少,这可能会导致合并后公司普通股股票价格和交易量的份额下降。
66
你目前作为ACIC普通股股东的权利与作为合并后公司普通股股东的权利之间将存在重大差异,其中一些可能会对你产生不利影响。
合并完成后,ACIC的股东将不再是ACIC的股东,而是合并后公司的股东。ACIC股东目前的权利与你作为合并后公司普通股股东所拥有的权利之间将存在重大差异,其中一些可能会对你产生不利影响。有关ACIC股东和合并后公司股东权利差异的更详细讨论,请参阅本委托书/招股说明书中标题为“普通股股东权利比较”的部分。
合并后,合并后的公司或其股东在公开市场上的未来出售或对未来出售的看法可能导致合并后公司普通股的市场价格下跌。
在公开市场上出售合并后公司的普通股,或认为这种出售可能发生,可能会损害合并后公司普通股的现行市场价格。这些出售,或这些出售可能发生的可能性,也可能使合并后的公司更难以在其认为适当的时间和价格出售股本证券。
在完成业务合并后,目前预计合并后公司将有总计23568155股合并后公司普通股未发行(不包括ACIC认股权证的行使,并假定ACIC的公众股东没有就业务合并赎回任何股份)。ACIC公众股东目前持有的所有股份,以及在企业合并中向现有GIO证券持有人发行的所有股份,均可自由交易,无需根据《证券法》进行登记,且不受合并后公司的“关联公司”(根据《证券法》第144条(“第144条”)的定义)以外的人的限制,包括合并后公司的董事、执行官和其他关联公司。
在执行和交付《企业合并协议》的同时,GIO的某些股东(根据上述假设和GIO目前的持股情况)预计将合计拥有合并后公司已发行普通股的约80.3%,他们同意,在自合并结束之日起至合并结束之日(x)一(1)周年和(y)在合并结束之日(A)ACIC普通股的收盘价等于或超过每股12.00美元(按股票分割调整)之日止的期间内,以较早者为准,股票股息、重组、资本重组等)自收盘后至少一百八十(180)天或(B)ACIC完成清算、合并、股本交换、重组或其他类似交易之日起的任何30个交易日内的任何二十(20)个交易日,这些交易导致买方的所有股东有权:(i)出借、要约、质押、质押、抵押、担保、捐赠、转让、出售、合同出售、出售任何购买期权或合同,购买任何出售期权或合同,授予任何购买期权、权利或保证,或以其他方式转让或处置,直接或间接地,任何受限证券,(ii)订立任何互换或其他安排,将此类受限证券所有权的任何经济后果全部或部分转移给另一方,或(iii)公开披露进行上述任何交易的意图,无论上述第(i)或(ii)条所述的任何此类交易是通过以现金或其他方式交付受限证券或其他证券来结算的(在每一种情况下,受限于某些有限的允许转让,如果接收方获得受锁定协议限制的股份)。见“提案1:企业合并提案——相关协议——锁定协议”。
此外,根据激励计划为未来发行而保留的合并后公司普通股股份,一旦发行,将有资格在公开市场上出售,但须遵守任何适用的归属要求、锁定协议和法律规定的其他限制。在企业合并完成后,预计将保留占合并后公司普通股完全稀释流通股10%的股份总数,以供未来根据激励计划发行。合并后的公司应根据《证券法》在表格S-8上提交一份或多份登记声明,以登记合并后公司的普通股或可转换为或可交换为根据激励计划发行的合并后公司普通股的证券。任何此种S-8表格登记声明将在提交时自动生效。因此,根据这种登记声明登记的股票将可在公开市场上出售。
今后,合并后的公司也可以发行与投资或收购有关的证券。因投资或收购而发行的合并公司普通股的股份数额可能构成合并公司普通股当时未发行股份的重要部分。任何与投资或收购有关的额外证券的发行都可能导致合并后公司股东的额外稀释。
67
ACIC目前是,合并后的公司也将是《证券法》所指的“新兴成长型公司”。如果合并后的公司利用新兴成长型公司在披露要求方面的某些豁免,这可能会降低ACIC的证券对投资者的吸引力,并可能增加将ACIC的业绩与其他上市公司进行比较的难度。
ACIC目前是一家经JOBS法案修订的《证券法》所指的“新兴成长型公司”。合并后的公司可继续利用适用于非新兴成长型公司的其他上市公司的各种报告要求的某些豁免,包括但不限于不被要求遵守《萨班斯-奥克斯利法》第404节的审计师证明要求,减少定期报告和代理声明中有关高管薪酬的披露义务,以及豁免要求就高管薪酬举行不具约束力的咨询投票和股东批准以前未获批准的任何金降落伞付款。因此,合并后的公司股东可能无法获得他们认为重要的某些信息。我们无法预测投资者是否会发现合并后公司发行的证券不那么有吸引力,因为合并后公司将依赖这些豁免。如果某些投资者由于依赖这些豁免而发现这些证券不那么有吸引力,合并后公司的证券的交易价格可能会低于其他情况,合并后公司的证券的交易市场可能会不那么活跃,合并后公司的证券的交易价格可能会更不稳定。
此外,《JOBS法》第102(b)(1)条规定,新兴成长型公司无需遵守新的或经修订的财务会计准则,直至私营公司(即那些没有宣布生效的《证券法》登记声明或没有根据《交易法》登记的证券类别的公司)必须遵守新的或经修订的财务会计准则。JOBS法案规定,公司可以选择退出延长的过渡期,并遵守适用于非新兴成长型公司的要求,但任何选择退出的选择都是不可撤销的。ACIC选择不选择退出这种延长的过渡期,这意味着当一个标准发布或修订,而它对上市公司或私营公司的申请日期不同时,合并后的公司作为一家新兴成长型公司,可以在私营公司采用新的或修订的标准时采用新的或修订的标准。这可能会使合并后公司的财务报表与另一家既不是新兴成长型公司也不是选择不使用延长过渡期的新兴成长型公司的上市公司进行比较变得困难或不可能,因为所使用的会计准则可能存在差异。
合并后的公司仍将是一家新兴成长型公司,直至下列最早日期:(一)首次公开发行结束五周年之后的财政年度的最后一天;(二)合并后的公司年度总收入至少为12.35亿美元的财政年度的最后一天;(三)合并后的公司被视为《交易法》第12b-2条所界定的“大型加速申报人”的财政年度的最后一天,如果非关联公司持有的合并后公司普通股的市值在该年度第二财政季度的最后一个营业日超过7亿美元,或(iv)合并后公司在前三年期间发行的不可转换债务证券超过10亿美元之日,就会发生这种情况。
合并后的公司可在行使未到期的公开认股权证之前,在对认股权证持有人不利的时间赎回这些认股权证。
合并后的公司将有能力在可行使的公开认股权证到期之前的任何时间,以每份认股权证0.01美元的价格赎回未偿还的公开认股权证,条件是合并后公司普通股的最后报告销售价格等于或超过每股18.00美元(可根据拆分、股息、资本重组和其他类似事件进行调整),在合并后公司向认股权证持有人发出赎回通知之日前的第三个营业日结束的30个交易日内的任何20个交易日内。当合并后的公司可赎回公开认股权证时,合并后的公司可行使其赎回权,条件是现有的登记声明对合并后的公司普通股的股份有效。赎回尚未赎回的公开认股权证可能会迫使你:(i)在可能对你不利的时候行使你的认股权证并支付相关的行使价格;(ii)在你可能希望持有你的认股权证时以当时的市场价格出售你的认股权证;或(iii)接受在要求赎回尚未赎回的公开认股权证时很可能大大低于你的认股权证的市场价值的名义赎回价格。任何私人认股权证只要由保荐人或其获准受让人持有,合并后的公司将不能以现金赎回。
68
如果合并后的公司决定赎回公开认股权证,我们的可赎回认股权证的持有人将会被通知我们的认股权证协议中所述的赎回。具体而言,如果本公司选择按上述方式赎回所有可赎回认股权证,本公司将确定认股权证的赎回日期。赎回通知书将由合并后的公司在认股权证赎回日期前不少于30天,以预付邮资的第一类邮件,寄往将予赎回的认股权证的登记持有人在登记簿册上的最后地址。以手令协议所规定的方式邮寄的任何通知,将被最终推定为已妥为发出,不论注册持有人是否收到该通知。此外,可赎回认股权证的实益拥有人将通过合并后的公司向DTC发出赎回通知而获得赎回通知。截至2023年[·],公众股份的收盘价为[·]美元,从未超过18.00美元的门槛,这将触发在收盘后赎回公开认股权证的权利。
与赎回有关的风险
不能保证公众股东决定是否按信托账户的比例赎回其公众股份将使该股东处于更有利的未来经济地位。
我们不能向你保证,在企业合并完成后,公众股东将来能够以什么价格出售合并后公司的普通股。任何企业合并(包括企业合并)完成后发生的某些事件可能导致合并后公司的股价上涨,并可能导致现在实现的价值低于ACIC股东在未来可能实现的价值,如果该股东没有选择赎回该股东的公众股份。同样,如果公众股东不赎回该股东的股份,则该股东将在企业合并完成后承担合并后公司普通股股份所有权的风险,并且不能保证合并后公司股东将来能够以高于本代理声明/招股说明书中规定的赎回价格的价格出售该股东的合并后公司普通股股份。ACIC公众股东应向该股东自己的税务或财务顾问咨询,以了解这可能如何影响其个人情况。
如果ACIC公众股东未能遵守本委托书/招股说明书中规定的赎回要求,他们将无权按信托账户所持资金的比例赎回其公众股份。
ACIC打算遵守美国联邦代理规则,进行与企业合并有关的赎回。然而,尽管ACIC遵守了这些规定,但如果ACIC股东未能收到ACIC的代理材料,该股东可能不会意识到有机会赎回其公众股份。此外,本委托书/招股说明书提供了有效投标或赎回公众股份所必须遵守的各种程序。如果公众股东不遵守这些程序或任何其他程序,其公众股份不得赎回。
为了行使其赎回权,公众股东必须在特别会议投票之前,通过存托信托公司的DWAC系统以实物或电子方式将其公开股份交付给ACIC的转让代理人。如果公众股东按照本委托书/招股说明书中的描述正确地寻求赎回,并且完成了业务合并,ACIC将按比例赎回这些公众股份,以换取存入信托账户的资金,并且在合并后公众股东将不再拥有这些公众股份。有关如何行使赎回权的更多信息,请参阅题为“股东特别会议——赎回权”的部分。
如果你或你所参与的ACIC股东的一个“团体”被视为合计持有超过15%的公众股份,你(或者,如果该团体的一名成员,或该团体的所有成员合计持有超过15%的公众股份)将失去赎回所有该等公众股份的能力。
公众股东,连同该股东的任何关联公司或与其一致行动的任何其他人,或作为“集团”(定义见《交易法》第13(d)(3)条),将被限制在未经ACIC事先同意的情况下赎回该股东的合计公众股份,或(如果是该集团的一部分)该集团超过公众股份15%的公众股份。然而,ACIC股东投票支持或反对企业合并提案的所有公众股份(包括这些超额股份)的能力不受这一赎回限制的限制。如果你在公开市场交易中出售这些多余的公开股票,你无法赎回任何这些多余的公开股票,可能会使你在ACIC的投资蒙受重大损失。ACIC不能向你保证,在企业合并后,这些多余的公众股份的价值将随着时间的推移而升值,或者公众股份的市场价格将超过每股赎回价格。
69
与ACIC相关的风险
公众股东对信托账户资金的权利或利益有限。因此,如果公众股东清算其投资,他们可能会被迫出售公众股份,这可能是亏本的。
公众股东将有权从信托账户获得资金:(a)因为他们持有公众股份,或(b)他们通过ACIC单位持有公众股份,并在行使公众股份赎回权之前选择将这些公众股份单位分离为基础公众股份和认股权证,只有在(i)这些公众股东行使与ACIC的初始业务合并(即业务合并)有关的赎回权时,如果发生),则仅涉及该公众股东正确选择赎回的公众股份,或(ii)如果ACIC无法在2023年8月14日之前完成初始业务合并,则赎回公众股份,但须遵守适用法律并在此进一步说明。此外,如果ACIC无法在2023年8月14日之前完成初始业务合并,遵守适用法律和现行章程可能会导致ACIC的清盘延迟,并可能要求ACIC在分配ACIC信托账户中持有的收益之前向当时的股东提交解散计划,以供批准。在这种情况下,公共股东可能被迫等到2023年8月14日之后才能从信托账户收到资金。在任何其他情况下,公众股东都不会对信托账户拥有任何权利或利益。因此,为了清算你的投资,公众股东可能会被迫出售他们的公众股份,可能会亏损。
ACIC的独立注册会计师事务所的报告中有一个解释性段落,对其作为“持续经营”的持续经营能力表示了严重怀疑。
截至2022年12月31日,ACIC的信托现金约为16182549美元,营运资金赤字为63692美元。此外,ACIC为执行其融资和收购计划,包括业务合并,已经发生并预计将继续发生重大费用。ACIC无法向您保证,它筹集资金或完成初始业务合并(包括业务合并)的计划将会成功。除其他外,这些因素使人们对其能否继续作为一个持续经营的企业产生了很大的怀疑。本代理声明/说明书其他部分所载的财务报表不包括因其无法完成业务合并或无法继续作为经营中企业而可能引起的任何调整。
公众股份持有人可能对第三方对ACIC的索赔承担责任,但以他们在赎回股份时收到的分配为限。
保荐人已同意,如果ACIC在企业合并完成前清算信托账户,它将有责任向ACIC的企业或供应商或其他实体支付债务和义务,这些企业或供应商或其他实体因ACIC提供的服务或与ACIC签订的合同或向ACIC出售的产品而欠下的款项,超过ACIC首次公开发行未在信托账户中持有的净收益,并且不会要求偿还这些费用,但仅限于确保此类债务或义务不会使信托账户中的数额低于每股10.20美元所需的范围内,且仅限于此类当事方未签署放弃协议的情况下。但是,不能保证如果要求它履行这些义务,它将能够履行这些义务。
如果ACIC被迫提起破产诉讼,或ACIC被提起非自愿破产诉讼但未被驳回,根据适用的债务人/债权人或破产法或破产法,公众股东收到的任何分配都可能被视为“优先转让”,即“欺诈性优先、转让或处分”。因此,破产法庭可以寻求追回ACIC公众股东收到的所有款项。此外,由于ACIC打算在ACIC完成初始业务合并的期限届满后,立即将信托账户中持有的收益分配给ACIC的公众股东,这可能被视为或被解释为在获取或分配ACIC资产方面,ACIC的公众股东优先于任何潜在债权人。此外,ACIC董事会可能被视为违反了其对ACIC或ACIC债权人的受托责任,或存在恶意行为,从而使自己和ACIC面临惩罚性赔偿要求,即在处理债权人的索赔之前从信托账户向公众股东支付赔偿金。由于这些原因,不能保证不会对ACIC提出索赔。
虽然ACIC寻求让所有供应商、服务提供商(独立注册会计师事务所和IPO承销商除外)或与其有业务往来的其他实体与ACIC签署协议,放弃为ACIC公众股东的利益对信托账户中的任何款项或对其持有的任何款项的任何权利、所有权、权益或任何种类的债权,以及向公众股东进行分配,但这些方不得签署此类协议,或者,即使他们执行了这些协议,也不得阻止他们向公共股东提出索赔或对放弃的可执行性提出质疑。
70
如果第三方对ACIC提出索赔,信托账户中的收益可能会减少,公众股东收到的赎回价格可能低于每股[·]美元。
ACIC将资金存入信托账户,可能无法保护这些资金免受第三方对ACIC的索赔。尽管ACIC寻求让所有供应商、服务提供商(独立注册会计师事务所和IPO承销商除外)或与其有业务往来的其他实体与ACIC签署协议,放弃为ACIC的公众股东对信托账户中的任何款项或对其持有的任何款项的任何权利、所有权、权益或任何种类的索偿,但这些当事人不得签署此类协议,或者即使他们签署了此类协议,也不得阻止他们对信托账户提出索偿,包括但不限于欺诈性诱导,违反受托责任或其他类似的索赔,以及对放弃的可执行性提出质疑的索赔,在每一种情况下都是为了在针对ACIC资产(包括信托账户中的资金)的索赔中获得好处。如果任何第三方拒绝签署协议,放弃对信托账户所持资金的此类债权,ACIC的管理层将对其可用的替代方案进行分析,并且只有在管理层认为第三方的参与对ACIC的好处明显大于任何替代方案的情况下,才会与未执行豁免的第三方签订协议。保荐人签订的协议明确规定了其所提供的赔偿的两个例外情况:它不承担以下责任:(1)对所欠目标企业或供应商或已与我们签订协议的其他实体的任何索赔金额,放弃他们在信托账户中或对信托账户中持有的任何款项可能拥有的任何权利、所有权、利息或任何类型的索赔,或(2)对IPO承销商针对某些责任(包括《证券法》规定的责任)提出的任何赔偿要求。ACIC的独立注册会计师事务所Marcum LLP和此次IPO的承销商不会与ACIC签署协议,放弃对信托账户中资金的此类债权。
ACIC可能聘用拒绝执行豁免的第三方的例子包括聘用第三方顾问,管理层认为该第三方顾问的专长或技能明显优于同意执行豁免的其他顾问,或在管理层无法找到愿意执行豁免的服务提供者的情况下。此外,不能保证这些实体同意放弃它们将来因与ACIC的任何谈判、合同或协议而可能拥有的任何债权,也不能以任何理由向信托账户寻求追索。在ACIC的公众股份被赎回时,如果ACIC无法在规定的时间框架内完成其初始业务合并,或者在行使与业务合并有关的赎回权时,ACIC将被要求为未被放弃的债权人在赎回后十年内可能对ACIC提出的债权提供偿付。因此,公共股东收到的赎回价格可能低于截至2023年[·]信托账户中因这些债权人的债权而持有的[·]美元。在这种情况下,ACIC可能无法完成初始业务合并,而你将因赎回你的公众股份而获得较少的每股收益。
保荐人已同意,如果ACIC在企业合并完成之前清算信托账户,它将有责任确保信托账户中的收益不会因目标企业的债权或供应商或其他实体的债权而减少,这些供应商或其他实体因我们提供或签约的服务或销售给ACIC的产品而被拖欠款项。因此,如果目标企业或供应商提出的索赔不超过信托账户以外ACIC可动用的资金数额,或信托账户余额所赚取的利息可向ACIC发放的资金数额,担保方将没有义务赔偿这些索赔,因为这些索赔将由这些可用资金支付。但是,如果一项索赔超过了这些数额,担保方支付这种索赔的义务的唯一例外情况是,当事人签署了一项协议,放弃其对信托账户中的任何款项或对信托账户中的任何款项拥有的任何权利、所有权、利息或任何种类的索赔。ACIC没有要求保荐人保留任何金额以履行可能产生的任何赔偿义务,预计其唯一资产将是ACIC的证券。因此,ACIC认为,如果要求担保人履行这些赔偿义务,它不太可能履行这些义务。因此,ACIC不能向您保证,如果我们清算信托账户,因为ACIC没有在规定的时间内完成业务合并,来自信托账户的每股分配将不低于10.20美元。
ACIC的董事可能会决定不执行保荐人根据内幕交易协议承担的赔偿义务,从而导致信托账户中可分配给ACIC公众股东的资金减少。
保荐人已同意,如果ACIC在企业合并完成之前清算信托账户,它将有责任确保信托账户中的收益不会因目标企业的债权或供应商或其他实体的债权而减少,这些供应商或其他实体因我们提供或签约的服务或销售给ACIC的产品而被拖欠款项。
如果保荐人声称其无法履行其义务,或者它没有与某项索赔相关的赔偿义务,ACIC的独立董事将决定是否对保荐人采取法律行动以执行其赔偿义务。虽然ACIC目前预计其独立董事将代表ACIC对保荐人采取法律行动,以执行其对ACIC的赔偿义务,但ACIC的独立董事在行使
71
他们的商业判断在任何特定情况下都可以选择不这样做。如果ACIC的独立董事选择不执行这些赔偿义务,信托账户中可分配给ACIC公众股东的资金可能会减少。
如果在ACIC将信托账户中的收益分配给其公众股东后,ACIC提出破产或清盘申请,或针对ACIC提出非自愿破产或清盘申请但未被驳回,破产或其他法院可能会寻求追回这些收益,ACIC董事会成员可能会被视为违反了对ACIC债权人的受托责任,从而使ACIC董事会成员和ACIC成员面临惩罚性赔偿要求。
如果在ACIC将信托账户中的收益分配给其公众股东后,ACIC提出破产或清盘申请,或者针对ACIC提出非自愿破产或清盘申请但未被驳回,根据适用的债务人/债权人或破产法,股东收到的任何分配可能被视为“优先转让”或“欺诈性转让、优先或处分”。因此,破产法庭可以寻求追回ACIC股东收到的所有款项。此外,ACIC董事会可能被视为违反了其对ACIC债权人的受托责任,或存在恶意行为,从而使自己和ACIC面临惩罚性赔偿要求,在处理债权人的索赔之前,通过信托账户向公众股东支付赔偿金。
法律或条例的变化,或不遵守任何法律和条例,都可能对ACIC的业务,包括其完成业务合并的能力和经营结果产生不利影响。
ACIC受国家、地区和地方政府颁布的法律和法规的约束。特别是,ACIC必须遵守某些SEC和其他法律要求。遵守和监测适用的法律和条例可能是困难、费时和昂贵的。这些法律和条例及其解释和适用也可能不时发生变化,这些变化可能对ACIC的业务、投资和业务结果产生重大不利影响。此外,如果不遵守解释和适用的适用法律或条例,可能对ACIC的业务产生重大不利影响,包括其完成业务合并的能力和业务结果。
ACIC尚未发行的认股权证可能会对普通股的市场价格产生不利影响,或对公众股东造成稀释。
ACIC已发行认股权证,将导致发行更多的普通股。此类证券在转换或行使后,将增加已发行和未发行普通股的数量。认股权证所涉股票的出售,甚至出售的可能性,都可能对ACIC证券的市场价格产生不利影响。如果这些认股权证被转换或行使,ACIC的公众股东的持股可能会被稀释。
ACIC管理层要求ACIC可赎回认股权证持有人在无现金基础上行使此类可赎回认股权证的能力,将导致持有人在行使可赎回认股权证时获得的普通股股份少于他们在能够以现金行使可赎回认股权证时获得的普通股股份。
如果ACIC在满足本委托书/招股说明书其他部分所述的赎回标准后要求ACIC赎回其认股权证,ACIC管理层将有权要求任何希望行使其认股权证(包括保荐人或其获准受让人持有的任何认股权证)的持有人在“无现金基础上”行使其认股权证。如果ACIC管理层选择要求持有人在无现金的基础上行使其认股权证,那么持有人在行使认股权证时获得的普通股数量将少于该持有人行使认股权证获得现金的数量。这将降低持有人在ACIC投资的潜在“上升空间”。
《萨班斯-奥克斯利法》规定的遵约义务可能使ACIC更难实施业务合并,需要大量财政和管理资源,并增加完成收购的时间和成本。
《萨班斯-奥克斯利法》第404节要求行政协调会评估和报告其内部控制制度。在初始业务合并后,如果本公司被视为大型加速申报人或加速申报人,将被要求遵守独立注册会计师事务所对其财务报告内部控制的认证要求。此外,只要本公司仍是一家新兴成长型公司,就无需遵守独立注册会计师事务所对其财务报告内部控制的认证要求。在业务合并之后,公司将被要求确保遵守《萨班斯-奥克斯利法》关于
72
其内部控制是否充分。为遵守《萨班斯-奥克斯利法》而发展内部控制系统的需要,可能会增加完成业务合并所需的时间和成本,并在业务合并后规定公司的义务。
美国证交会最近发布了监管特殊目的收购公司的拟议规则。就这类建议可能采取的某些程序可能会增加完成业务合并所需的费用和时间,并可能限制完成业务合并的情况。
2022年3月30日,SEC发布了拟议规则(“SPAC规则提案”),除其他事项外,这些规则涉及SEC备案文件中与美国等特殊目的收购公司与私营运营公司之间的企业合并交易相关的披露;适用于涉及空壳公司的交易的财务报表要求;SEC备案文件中与拟议企业合并交易相关的预测使用;拟议企业合并交易中某些参与者的潜在责任;以及SPAC可能在多大程度上受到1940年《投资公司法》的监管,经修订(《投资公司法》),其中包括一项拟议规则,如果SPAC满足某些限制SPAC期限、资产构成、业务目的和活动的条件,这些规则将为SPAC提供一个安全港,使其不被视为投资公司。SPAC规则提案尚未获得通过,可能会以提议的形式或可能对SPAC施加额外监管要求的其他形式获得通过。
与SPAC规则建议相关的某些程序,或根据SEC在SPAC规则建议中表达的观点,可能会增加谈判和完成业务合并的成本和时间,并可能使完成业务合并变得更加困难。遵守SPAC规则建议的需要可能会导致我们清算信托账户中的资金或在我们可能选择的更早时间清算。如果我们进行清算,我们的认股权证将到期时一文不值,我们的证券持有人将失去与对合并后公司的投资相关的投资机会,包括我们的证券的任何潜在价格升值。
如果根据1940年《投资公司法》,ACIC被视为一家“投资公司”,我们可能会被要求制定繁琐的合规要求,我们的活动可能会受到限制,这可能会使我们难以完成业务合并。
如果根据《投资公司法》,ACIC被视为一家投资公司,其活动可能受到限制,包括:
| ● | 对其投资性质的限制;及 |
| ● | 对其证券发行的限制,每一项都可能使我们难以完成业务合并。 |
此外,行政协调会可能对其提出了一些繁重的要求,包括:
| ● | 在美国证券交易委员会注册为投资公司; |
| ● | 采用特定形式的公司结构;和 |
| ● | 报告、记录保存、投票、代理和披露要求以及我们目前不受其约束的其他规则和规定。 |
为了不受《投资公司法》作为投资公司的监管,除非我们有资格被排除在外,我们必须确保我们主要从事的业务不是投资、再投资或证券交易,并且我们的活动不包括投资、再投资、拥有、持有或交易在未合并基础上占我们资产(不包括美国政府证券和现金项目)40%以上的“投资证券”。
我们认为,我们的主要活动和业务合并不会使我们受到《投资公司法》的约束。为此,信托账户中持有的收益只能投资于《投资公司法》第2(a)(16)节所指的期限为185天或更短的美国“政府证券”,或投资于符合《投资公司法》颁布的第2a-7条规定的某些条件的货币市场基金,这些基金只投资于美国政府的直接国库债务。根据信托协议,受托人不得投资于其他证券或资产。通过限制将收益投资于这些工具,并制定一项旨在为
73
长期而言(而不是以商业银行或私人股本基金的方式买卖企业),我们打算避免被视为《投资公司法》所指的“投资公司”。投资于我们的证券,并不是为寻求投资于政府证券或投资证券的回报的人士而设。信托帐户的目的是作为以下两种情况中最早出现的资金的存放地:(i)完成我们的初步业务合并(如发生合并,即为业务合并);(ii)赎回因股东投票修订我们的经修订的及经重订的成立法团证明书(A),以修订我们的责任的实质或时间安排,规定我们的普通股持有人有权就我们的首次业务合并(如发生合并,即为业务合并)赎回他们的股份,或在我们未能于八月十四日前完成首次业务合并时赎回我们的100%公众股份,2023年(可进一步延展)或(B)任何其他与普通股股东权利有关的条文;或(iii)在2023年8月14日(可进一步延展)之前,如没有首次业务合并(如发生合并,即为业务合并),我们将信托账户中的资金返还公众股东,作为我们赎回公众股份的一部分。如果我们不像上面讨论的那样投资收益,我们可能会被视为受《投资公司法》的约束。如果我们被认为受《投资公司法》的约束,遵守这些额外的监管负担将需要额外的费用,而我们没有为此拨出资金,这可能会妨碍我们完成业务合并的能力。如果我们无法完成业务合并,我们的公众股东只能收到信托账户中可分配给公众股东的按比例部分的资金,我们的认股权证将一文不值。
2022年3月30日,美国证交会发布了拟议的规则,其中包括SPAC在多大程度上可能受到《投资公司法》的监管。美国证交会根据《投资公司法》提出的规则,将为SPAC提供一个安全港,使其不受《投资公司法》第3(a)(1)(A)节中“投资公司”定义的约束,前提是它们满足某些限制SPAC期限、资产构成、业务目的和活动的条件。拟议中的安全港规则的期限部分将要求SPAC向欧盟委员会提交一份8-K表格的当前报告,宣布它已与目标公司(或多家公司)达成协议,在SPAC首次公开发行注册声明生效后的18个月内进行首次业务合并。然后,SPAC将被要求在其首次公开发行的注册声明生效后的24个月内完成其首次业务合并。尽管提议的安全港规则尚未被采纳,但美国证交会表示,《投资公司法》是否适用于未在提议的安全港规则规定的拟议时限内完成初始业务合并的SPAC,存在严重问题。
拟议的安全港规则尚未获得通过,拟议的安全港规则的一个或多个要素可能不会获得通过,或可能以修订的形式获得通过。然而,如果根据《投资公司法》的规定,我们被认为是一家投资公司,遵守这些额外的监管负担将需要额外的费用,而我们没有拨出资金,这可能会增加完成业务合并所需的成本和时间,或损害我们完成业务合并的能力。如果我们没有在规定的时间内完成我们的初始业务合并,我们的公众股东在清算我们的信托账户时可能只能得到大约每股[·]美元,或者在某些情况下更少,我们的认股权证将一文不值。
为降低我们被视为未注册投资公司的风险(包括根据《投资公司法》第3(a)(1)(A)条的主观测试),并因此受《投资公司法》规定的约束,我们可随时指示信托账户的受托人大陆集团清算信托账户中持有的美国政府国债或货币市场基金,然后将信托账户中的所有资金作为现金持有,直至我们的初始业务合并完成或ACIC清算完成(以较早者为准)。在这种清算之后,我们很可能会收到信托账户资金的最低利息,如果有的话。但是,以前在信托账户中持有的资金所赚取的利息仍然可以发放给我们,以支付我们的税款,如果有的话。因此,任何清算信托账户中所持投资并随后将信托账户中的所有资金以现金形式持有的决定,都将减少我们的公众股东在赎回或清算ACIC时获得的美元金额。
此外,即使在我们的IPO注册声明生效24个月之前,我们可能被视为一家投资公司。信托账户中的资金存放在短期美国政府国债或专门投资于此类证券的货币市场基金中的时间越长,甚至在24个月周年之前,我们被视为未注册投资公司的风险就越大,在这种情况下,我们可能需要清算ACIC。因此,我们可以酌情决定在任何时候清算信托账户中持有的证券,而将信托账户中的所有资金作为现金项目持有,这将进一步减少我们的公众股东在赎回或清算ACIC时将获得的美元金额。如果我们清算ACIC,我们的认股权证将到期时一文不值,而我们的证券持有人将
74
失去与投资于合并后公司相关的投资机会,包括我们的证券的任何潜在价格升值。
就特别会议而言,公众股东可能需要遵守赎回其公众股份的具体要求,这可能使公众股东更难在行使其权利的截止日期之前行使其转换权利。
对于为批准拟议的初始业务合并而召开的任何股东会议,每个公众股东将有权要求ACIC将其公众股份转换为信托账户的一部分,无论其投票赞成还是反对这种拟议的业务合并。ACIC可要求希望在拟议的业务合并中转换其公众股份的公众股东向转让代理提交其证书(如有)和赎回表格,或使用DTC的DWAC系统以电子方式将其股票证书(如有)和其他赎回表格交付给转让代理。为了获得实物股票证书,公众股东的经纪人或结算经纪人、DTC和转让代理将需要采取行动,为这一请求提供便利。ACIC的理解是,公众股东通常应至少分配两周时间从转让代理获得实物证书。然而,由于ACIC对这一过程或经纪人或DTC没有任何控制权,获得实物股票证书可能需要两周以上的时间。ACIC的理解是,通过DWAC系统交付股票需要很短的时间。然而,情况可能并非如此。因此,如果公众股东交付其股票(如果有的话)和其他赎回表格的时间超过ACIC的预期,希望转换的公众股东可能无法在最后期限前行使其转换权利,因此可能无法转换其公众股份。
如果ACIC要求希望转换其公众股份的公众股东遵守转换的交割要求,在拟议的企业合并未获批准的情况下,这些转换股东可能无法在他们希望出售其证券时出售其证券。
如果ACIC要求希望转换其公众股份的公众股东遵守上述转换的具体交割要求,而此类拟议的企业合并未完成,ACIC将立即将此类证书退还给投标的公众股东。因此,在这种情况下试图转换其股票的投资者将无法在收购失败后出售其证券,直到ACIC将其证券归还给他们。在此期间,ACIC股票的市场价格可能会下跌,ACIC的公众股东可能无法在他们希望的时候出售他们的证券,即使其他没有寻求转换的股东可能能够出售他们的证券。
纽约证交所已将我们的证券从其交易所退市,这可能会限制投资者对我们的证券进行交易的能力,并降低我们证券的流动性。
ACIC于2023年1月31日收到纽约证交所员工的书面通知,称ACIC没有遵守《纽约证交所上市公司手册》第802.01B节的规定,该节要求上市公司在连续30个交易日内保持其公开持股的全球平均总市值至少为40,000,000美元。纽约证券交易所还告知公司,由于未能遵守《市值要求》,纽约证券交易所决定启动程序,从纽约证券交易所摘牌公司的A类普通股、购买A类普通股的认股权证和单位,每个单位包括一股A类普通股和一份可赎回认股权证的二分之一(统称“公司证券”)。
2023年1月31日,纽约证券交易所发布新闻稿称,将摘牌该公司的证券,这些证券被立即暂停交易,自那时以来一直没有在纽约证券交易所交易。2023年2月15日,纽约证交所向美国证交会提交了一份表格25,以完成退市。除名在提交表格25十天后生效。ACIC的证券继续在OTC Pink Marketplace交易,股票代码分别为“APNCU”、“APNC”和“APNCW”。
由于我们从纽约证券交易所的交易中除名,我们可能面临不利后果,包括:
| ● | 我们证券的市场报价有限; |
| ● | 我们证券的流动性减少; |
| ● | 确定我们的普通股是一种“细价股”,这将要求交易我们普通股的经纪人遵守更严格的规则,并可能导致我们证券的交易活动减少; |
75
| ● | 有限的新闻和分析师报道;以及 |
| ● | a未来发行更多证券或获得更多融资的能力下降。 |
1996年的《国家证券市场改进法案》是一项联邦法规,它阻止或阻止各州对某些证券的销售进行监管,这些证券被称为“担保证券”。虽然各州在监管我们的证券销售方面处于领先地位,但联邦法规确实允许各州在涉嫌欺诈的情况下对公司进行调查,如果发现存在欺诈活动,那么各州可以在特定情况下监管或禁止担保证券的销售。虽然我们不知道有哪个州利用这些权力禁止或限制销售空白支票公司发行的证券,但某些州的证券监管机构对空白支票公司持不利态度,可能会利用这些权力,或威胁使用这些权力,来阻碍空白支票公司在本州的证券销售。此外,由于我们的证券已从纽约证券交易所退市,它们将不再被视为担保证券,并受我们提供证券的每个州的监管。
ACIC可能无法在2023年8月14日之前完成其首次业务合并,在这种情况下,除非批准对Current Charter的进一步修订以延长合并期,否则ACIC将停止除清盘外的所有业务,并赎回公众股份并进行清算。
ACIC可能无法在2023年8月14日之前完成与GIO的业务合并。ACIC完成初始业务合并的能力可能会受到一般市场状况、资本和债务市场波动以及本文所述其他风险的负面影响。如果ACIC没有在根据现行章程的修订完成初始业务合并的期限内或任何延长的期限内完成其初始业务合并,ACIC将(i)停止所有业务,但以清盘为目的,(ii)在合理可能的范围内尽快,但在其后不超过十个工作日,按每股价格赎回以现金支付的公众股份,等于当时存入信托账户的总金额,包括从信托账户持有的资金中赚取的利息(减去用于支付解散费用的不超过100,000美元的利息),除以当时已发行的公众股份的数量,根据适用法律,赎回将彻底取消公众股东作为股东的权利(包括获得进一步清算分配的权利,如果有的话),以及(iii)在赎回后在合理可能的范围内尽快,但须得到我们其余股东和董事会的批准,解散和清算,但在每一种情况下,我们都有义务根据特拉华州法律规定债权人的债权和其他适用法律的要求。
与税务有关的风险
美国或其他司法管辖区适用的税法、条例或行政解释的变化可能对ACIC产生不利影响。
ACIC还可能受到美国或其他司法管辖区适用税法、法规或行政解释变化的不利影响,税法变化可能会减少ACIC的税后收入,并对ACIC的业务和财务状况产生不利影响。例如,2017年12月颁布的通常被称为《减税和就业法案》(Tax Act)的美国联邦税收立法导致该法案发生了根本性的变化,其中包括降低联邦企业所得税税率、对企业利息支出的可扣除性进行部分限制、对某些董事和高管薪酬支出的可扣除性进行限制、对净经营亏损结转和结转的限制,以及与美国对国际业务收入征税的范围和时间有关的变化。随后于2020年3月27日颁布的《冠状病毒援助、救济和经济安全法》(简称“CARES法”)放宽了《税法》对某些纳税年度施加的某些限制,包括对净经营亏损的使用和结转的限制,以及对企业利息支出可抵扣的限制。《税法》和《CARES法》对未来几年的确切影响难以量化,但这些变化可能对我们、GIO、合并后的公司或我们或他们的子公司产生重大影响。此外,未来还可能出台其他改革措施,提高公司税率,进一步限制利息的扣除,或者实施其他可能对ACIC财务状况产生重大不利影响的改革。这些变化还可能包括增加州税和对州税法进行其他修改,以补充因新冠疫情造成的成本而耗竭的州和地方政府财政,以及随之而来的经济衰退导致的税收收入减少。
此外,ACIC的实际税率和纳税义务基于现行所得税法律、法规和条约的适用。这些法律、条例和条约很复杂,往往可以解释。未来,税务当局可能会质疑ACIC对法律、法规和条约的解释,从而导致额外的纳税义务或对ACIC的收入进行调整
76
可能提高ACIC有效税率的税收条款。税法的变化也可能对ACIC吸引和留住关键人才的能力产生不利影响。
与GIO业务相关的风险
与GIO有限的经营历史、财务状况和资本要求相关的风险
自成立以来,GIO出现了巨大的净亏损和负的经营现金流。GIO预计在可预见的未来将出现净亏损,并且可能永远不会实现或保持盈利。
GIO是一家以干细胞为基础的生命科学公司,运营历史有限。GIO的Treatments具有很强的投机性,因为它们需要大量的前期资本支出,而且存在很大的风险,即任何Treatments都无法证明足够的效果或可接受的安全性,无法获得监管机构的批准,也无法在商业上变得可行。迄今为止,GIO尚未从Treatment销售中获得任何收入。因此,GIO没有盈利,自成立以来每个时期都出现亏损和负经营现金流。截至2022年12月31日和2021年12月31日,GIO分别报告净亏损242096美元和1002美元。截至2022年12月31日和2021年12月31日,GIO报告的经营现金流分别为负数[·]百万美元和[·]百万美元。截至2022年12月31日,GIO的累计赤字为2.37674亿美元。GIO预计,在可预见的未来,将继续产生大量费用和不断增加的运营亏损,GIO预计,随着开始运营,这些亏损将会增加。
GIO产生的净亏损可能会在每个季度之间大幅波动。GIO预计,随着GIO开始运营,以及如果GIO:
| ● | 开始研究计划; |
| ● | 设法确定更多的治疗和研究方案; |
| ● | 启动GIO识别和开发的任何其他疗法的临床前测试和临床试验; |
| ● | 维护、扩展、执行、捍卫和保护GIO的知识产权组合; |
| ● | 为成功完成临床试验的任何疗法寻求营销批准; |
| ● | 最终建立销售、营销和分销基础设施,将GIO可能获得营销批准的任何Treatments商业化; |
| ● | 启动监管合规工作,纳入适用于任何经批准的治疗的要求; |
| ● | 聘用研发和临床人员; |
| ● | 雇用商业人员,推进市场准入和偿还战略; |
| ● | 增加运营、财务和管理信息系统和人员,包括支持GIO产品开发的人员; |
| ● | 从第三方取得或许可治疗、知识产权和技术,或根据知识产权许可支付专利使用费或其他付款义务; |
| ● | 开发或许可制造和分销技术; |
| ● | 如果GIO决定这样做并获得GIO的任何Treatments的批准,建造和维护,或购买和验证符合当前良好生产规范(“cGMP”)要求的商业规模生产设施;以及 |
| ● | 作为一家上市公司运营会产生额外的法律、会计和其他费用。 |
77
作为一家公司,GIO尚未参与任何Treatment的临床开发,并预计将需要几年时间(如果有的话),才能让Treatment实现商业化。为了获得并保持盈利,GIO必须直接或通过合作者开发并最终将具有巨大市场潜力的产品商业化。这将要求GIO在一系列具有挑战性的活动中取得成功,包括确定Treatments,完成Treatments的临床前测试和临床试验,获得这些Treatments的营销批准,制造、营销和销售其可能获得营销批准的Treatments,以及满足任何营销后要求。
GIO可能永远不会在这些活动中取得成功,即使它取得了成功,也可能永远不会产生足以实现盈利的可观或巨大的收入。GIO的治疗和研究项目尚未开始。由于与开发Treatments相关的众多风险和不确定性,GIO无法预测未来亏损的程度或何时盈利,如果有的话。如果GIO确实实现了盈利,它可能无法维持或提高每季度或每年的盈利能力。GIO未能实现并保持盈利将降低其公司的价值,并可能削弱其筹集资本、维持GIO的研发努力、扩大业务或继续GIO运营的能力。GIO的价值下降也可能导致你损失全部或部分投资。
GIO将需要大量额外资金,这些资金可能无法以可接受的条件获得,或者根本无法获得。如果GIO无法在需要时筹集资金,它将被迫推迟、减少或取消其研究和产品开发计划或未来的商业化努力。
GIO预计将花费大量现金开始其Treatments的研发和临床前测试及临床试验,在必要时为其Treatments寻求监管批准,并推出并商业化其获得监管批准的任何Treatments。此外,交割后,GIO预计将产生与作为上市公司运营相关的额外费用。因此,GIO将需要获得大量额外资金。如果GIO无法在需要时或以有吸引力的条件筹集资金,它将被迫推迟、减少或取消其未来的研究和产品开发计划或未来的商业化努力。截至2022年12月31日,GIO的现金及现金等价物为17791美元,累计赤字为237674美元。GIO未来的融资需求将取决于许多因素,包括:
| ● | GIO治疗的临床前研究和临床试验的启动、进展、时间、成本和结果(如果需要),或对其开发项目的其他影响; |
| ● | 构建GIO技术平台的成本,包括用于开发GIO Treatments的额外技术许可; |
| ● | 在美国和国际上准备、提交和起诉专利申请、维护和执行GIO的知识产权和专有权利以及为与知识产权相关的索赔进行辩护的费用; |
| ● | GIO开发或可能获得许可的Treatments的数量和特性; |
| ● | GIO在有利条件下建立和维持合作的能力(如果有的话); |
| ● | 实现里程碑或发生其他事态发展,触发根据其签订的任何合作协议付款; |
| ● | 满足FDA、欧洲医疗机构(“EMA”)和其他类似外国监管机构制定的监管要求的结果、时间和成本; |
| ● | 完成商业规模外包制造活动的成本和时间; |
| ● | 在GIO选择自行将其商业化的地区,为GIO可能获得监管批准的任何Treatments建立销售、营销和分销能力的成本;以及 |
| ● | 作为一家上市公司的运营成本。 |
如果GIO进行临床前测试和临床试验,这是一个耗时、昂贵和不确定的过程,需要数年才能完成,而且GIO可能永远不会产生获得市场批准和实现产品销售所需的必要数据或结果。
78
此外,即使GIO成功开发了Treatments,并且这些药物获得批准,GIO也可能不会取得商业成功。GIO的商业收入(如果有的话)将来自Treatments的销售,该公司预计未来几年都不会在商业上销售这些产品。因此,GIO将需要继续依靠额外的资金来实现其业务目标。
任何额外的筹资努力都可能使GIO的管理层从日常活动中分心,这可能会对GIO开发和商业化Treatments的能力产生不利影响。GIO不能确定是否会以可接受的条件提供额外资金,或者根本不能确定。GIO没有承诺的额外资本来源,如果GIO无法筹集足够数额的额外资本或以其可接受的条件筹集额外资本,它可能不得不大幅推迟、缩减或停止Treatments或其他研发计划的开发或商业化。如果GIO无法履行协议规定的付款或其他义务,GIO的许可协议和任何未来的合作协议也可能被终止。GIO可能被要求在更早的阶段为Treatments寻找合作者,否则将是可取的,或者以不那么有利的条件寻找合作者,或者以不利的条件放弃或许可其在市场上的Treatments权利,否则它将寻求自身的开发或商业化。
由于GIO的经常性经营亏损和经常性经营活动产生的负现金流,GIO的财务报表中包含了一项声明,即对其维持足够流动性以有效运营其业务的能力存在重大疑问,这对GIO的持续经营能力提出了重大疑问。请参阅下面标题为“由于GIO的历史亏损和经营活动产生的负现金流,其财务报表包含对GIO持续经营能力存在重大疑问的声明”的风险因素。如果GIO无法及时获得资金,它可能会被要求大幅削减、延迟或终止GIO的一个或多个研发项目或任何治疗的商业化,或者无法按要求扩大GIO的业务或以其他方式利用GIO的商业机会,这可能会对其业务、财务状况和经营业绩产生重大影响。上述任何事件都可能严重损害GIO的业务、前景、财务状况和经营业绩,并导致GIO普通股价格下跌。
GIO从未从产品销售中获得收入,也可能永远不会盈利。
GIO从产品销售中获得收入并实现盈利的能力,取决于它单独或与合作者成功完成Treatments开发并获得商业化所需的监管批准的能力。GIO预计未来几年(如果有的话)不会从产品销售中获得收入。GIO未来从产品销售中获得收入的能力,在很大程度上取决于其(或其未来合作者)能否成功:
| ● | 确定治疗,完成GIO可能确定的任何治疗的研究和临床前和临床开发; |
| ● | 为GIO完成临床试验的任何疗法寻求并获得监管和营销批准; |
| ● | 通过建立销售队伍、营销和分销基础设施或与商业化合作伙伴合作,推出GIO获得监管和营销批准的任何Treatments并将其商业化; |
| ● | 对于GIO获得监管和营销批准的任何治疗,有资格获得政府和第三方支付方的覆盖和充分补偿; |
| ● | 为GIO可能开发的Treatments开发、维护和改进可持续、可扩展、可复制和可转移的制造工艺; |
| ● | 与第三方建立并维持供应和制造关系,能够在数量和质量上提供足够的治疗,以支持GIO获得监管和营销批准的任何治疗的临床开发和市场需求; |
| ● | 获得市场认可的治疗作为可行的治疗选择; |
| ● | 应对相互竞争的技术和市场发展; |
| ● | 视需要实施内部系统和基础设施; |
79
| ● | 在GIO可能参与的任何合作、许可或其他安排中谈判有利条件,并履行其在此类安排中的义务; |
| ● | 维护、保护、执行、捍卫和扩大GIO在美国和国际上的知识产权组合; |
| ● | 在美国和国际上避免和抗辩第三方干预、侵权和其他知识产权索赔;以及 |
| ● | 吸引、雇用和留住合格的人才。 |
即使GIO开发的一种或多种疗法被批准用于商业销售,它预计也会产生与任何批准的候选产品商业化相关的大量成本。如果FDA、EMA或其他监管机构要求GIO在目前预期的基础上开展临床和其他研究,GIO的支出可能会超出预期。
上面列出的许多因素都超出了GIO的控制范围,可能会导致GIO遭遇重大延误,或阻止GIO完成其Treatments的开发、获得监管批准或将其Treatments商业化。即使GIO确实实现了盈利,它也可能无法维持或提高每季度或每年的盈利能力。未能实现或保持盈利可能导致公司价值下降,也可能导致你损失全部或部分投资。
由于GIO的历史亏损和经营活动产生的负现金流,其财务报表包含一份声明,说明对其持续经营能力存在重大疑问。
经营亏损和经营活动产生的负现金流的历史,再加上GIO预计将使用现金为经营活动提供资金,令人对该公司能否在截至2022年12月31日止年度未经审计的中期简明财务报表发布之日起的12个月内继续作为持续经营企业产生重大怀疑。作为一家持续经营的企业,GIO未来的生存能力取决于其从经营活动中产生现金或筹集额外资金为其运营提供资金的能力。
认为GIO可能无法继续作为经营中企业经营的看法,也可能使其更难以以对其有利的条件或根本无法获得继续经营的资金,并可能导致投资者和雇员丧失信心。GIO的财务报表不包括这种不确定性可能导致的任何调整。如果GIO无法持续经营,它可能不得不清算其资产,并可能获得低于这些资产在其财务报表中的价值,GIO的投资者很可能会损失全部或部分投资。
GIO有限的运营历史使得评估其业务和未来前景变得困难,并可能增加你投资的风险。
迄今为止,GIO的业务主要集中在Treatments的设计和开发上。该公司尚未获得监管部门的批准,以启动商业制造和销售,建立大规模的内部或第三方制造能力,发展销售和分销网络,或出售其Treatments。如果GIO要取得成功,它将面临一系列运营挑战,包括:
| ● | 以令人满意的条件(如果有的话)为研究、开发、制造、营销和销售等方面的投资获得足够的资本; |
| ● | 成功启动其Treatments的商业生产和销售; |
| ● | 建立和扩大客户基础,并建立一个公认的品牌; |
| ● | 订立令人满意的制造商和供应商关系; |
| ● | 发展其销售和分销网络; |
| ● | 遵守复杂和不断变化的规章;以及 |
80
| ● | 预测和适应不断变化的市场条件。 |
GIO有限的运营历史并没有为投资者提供太多信息,来评估它在应对这些挑战方面能取得多大成功。与GIO早期运营相关的风险增加,导致投资者兴趣下降,股价和流动性下降。
Risks related to GIO’s Prospective Business and the development of its Treatments
GIO尚未开始计划中的业务项目活动,也没有将Treatments商业化的历史,这可能使其难以评估其未来可行性的前景。
GIO是一家处于收入前和发展阶段的公司。GIO成立于2021年,尚未开始运营其拟议的业务线。GIO尚未证明有能力成功完成临床试验;获得营销批准;制造商业规模的药物或疗法,或安排第三方代表其这样做;或进行成功商业化所必需的销售和营销活动。因此,GIO对其未来成功或生存能力所做的任何预测,可能都不像GIO有运营历史时那么准确。
GIO计划在风险和不确定性较高的行业和领域开展多个业务线。这使得评估GIO未来的潜在价值和前景变得困难。
GIO计划在因各种因素而面临高度不确定性和风险的行业和领域开展业务线,包括在题为“风险因素”的本节其他部分和本代理声明/招股说明书其他部分所述的行业和领域。GIO从Treatments开发并产生收入的计划可能无法按计划实现,或者GIO的计划可能会因各种已知和未知的原因而改变,其中许多原因不在GIO的控制范围内,无法预测,这些因素和其他因素可能导致业务、运营、计划和结果与GIO的计划存在重大差异。
GIO可能无法建立其计划的部分或全部业务线,或者如果它能够建立和执行这些业务线,则部分或全部业务线可能不会成功。
GIO可能无法开发或建立GIO计划中的部分或全部业务线,或者,如果GIO按照本代理声明/招股说明书中所述的业务线开展业务,则无法保证GIO将能够从中产生收入或成功地与从事类似业务的其他公司竞争。一些业务线的发展可能依赖于其他产生收入的业务线。如果GIO无法在一个或多个业务线产生收入,GIO计划中的其他业务线可能会受到影响,或者缺乏足够的资金来开发。
GIO预计,其治疗的开发将需要大量的时间和物质资源,而GIO可能无法获得这些资源。
GIO预计将需要大量的时间和物力资源来成功开发其计划的业务线。例如,对于GIO的抗衰老诊所业务,GIO预计将在以下领域支出:招聘人员、确定地点以及租赁或获取空间,包括实验室设施、办公空间、医疗设备以及抗衰老诊所的其他费用、差旅、保险、合规和许可证相关费用以及法律费用。拥有和经营抗衰老诊所,或参与与诊所合作伙伴就抗衰老诊所达成的伙伴关系安排,可能会产生其他成本,GIO预计会产生与这一业务相关的某些负债,其中一些可能是重大的。GIO还预计,除其他费用外,GIO可能需要为此类活动获得专门或补充保险,而此类保险可能无法以优惠条件提供。
GIO预计,设计和建造一个原型生物反应器将产生大量成本。虽然尚不清楚这种原型生物反应器何时能完工,但GIO预计,从开始建造之日起,建造过程将持续一年多。此外,如果GIO成功构建了一个原型生物反应器,并且这种原型生物反应器产生了积极的结果,GIO预计将花费大量资源寻求FDA的批准。
GIO还预计将产生与其Active Cosmetics业务线相关的费用,包括GIOSTAR供应协议项下的费用以及与AHSDM营销相关的费用。
81
GIO拟议的三个业务线本质上是前瞻性的,GIO可能会同时或依次对三个拟议业务线的部分或全部,或部分或全部的方面进行进一步开发。
GIO拟议的三个业务线本质上是前瞻性的,GIO可能会同时或依次对三个拟议业务线的部分或全部,或部分或全部的方面进行进一步开发。追求一个业务线可能需要管理层比其他业务线更多的时间和注意力,这可能导致一些业务线的发展速度变慢。此外,某些业务线可能需要比其他业务线更多的资本支出,这可能会给其他业务线留下更少的资源。
GIO未来潜在的抗衰老诊所业务能否成功,可能部分或完全取决于第三方诊所所有者/经营者。
我们希望我们的一些抗衰老诊所将由第三方拥有和/或经营。由于我们不会拥有和/或经营这些诊所,第三方所有者成功开设和经营这些诊所的能力将影响我们的盈利能力。第三方成功开设和经营诊所的能力将取决于许多因素,其中包括:
| ● | 为诊所招聘合格的保健从业人员; |
| ● | 雇用、培训和留住保健从业人员和其他人员; |
| ● | 保持充分的信息系统和其他操作系统能力; |
| ● | 在适当地点谈判可接受的租赁条款的能力; |
| ● | 以可接受的费用采购足够数量的医疗用品; |
| ● | 取得和保持必要的许可证和执照;和 |
| ● | 获得并保持品牌知名度; |
由于我们无法完全控制第三方所有者/经营者如何经营和管理他们的诊所,他们未能有效应对此类挑战可能会对GIO的业务、财务状况、经营业绩和前景产生重大不利影响。
GIO的某些管理人员和董事由于在GIOSTAR或其他业务中的利益或职位,可能与他们对GIO的责任或与GIO的责任存在实际或潜在的利益冲突。
GIO的首席执行官兼董事Patel先生和GIO的首席科学官兼董事Srivastava博士目前分别担任并将在业务合并完成后继续担任GIOSTAR的首席执行官和首席科学官。因此,帕特尔和斯里瓦斯塔瓦博士在GIO业务运营上投入的时间将少于全职时间。GIO预计,根据将在交易结束时签订的雇佣协议和非竞争协议,帕特尔和斯里瓦斯塔瓦博士将分别履行GIO首席执行官和CSO的职责,但不需要为GIO的业务提供每周或每月特定的工作时间。
GIO是否能够成功地或完全地开展这些业务,取决于Srivastava博士和Patel先生向GIOSTAR独家转让的与干细胞相关的商业秘密、技术诀窍和知识产权。GIOSTAR是由Srivastava博士和Patel先生控制并拥有多数股权的实体,而GIOSTAR又向GIO授予了独家许可(在有限的例外情况下),可在属于GIO四个业务部门的活动中使用此类商业秘密、技术诀窍和知识产权。根据这种安排,GIOSTAR可将这些商业秘密、专门知识和知识产权用于业务线以外的目的,或继续在哥斯达黎加、墨西哥和印度这三个国家拥有和经营抗衰老诊所,在这些国家,GIO将不享有从事这一业务线的专属权利。此外,除非GIO能够为化妆品或其他产品制造AHSDM或其他“活性成分”,否则如果GIO开发Active Cosmetics业务线,GIO预计将依赖根据GIOSTAR供应协议交付给GIO的AHSDM来启动和制定此类业务计划。如果GIOSTAR出于任何原因不履行其在GIOSTAR许可协议和排他性协议下的义务或遵守其条款,或Srivastava博士或Patel先生未能使GIOSTAR完全满足上述任何安排的条款和要求,包括在GIOSTAR的商业利益与
82
一方面是GIO或斯里瓦斯塔瓦博士和帕特尔,另一方面是GIO,GIO的业务和未来的招股说明书将受到重大不利影响。
帕特尔和斯里瓦斯塔瓦博士对GIOSTAR的参与和所有权,可能会在他们面临的决策中产生利益冲突,这些决策对GIOSTAR的影响可能不同于对GIO的影响。这些潜在的冲突可能会产生,例如,GIO的业务和运营、资金和资本事项、监管事项、与知识产权相关的冲突,包括与GIOSTAR授权给GIO的技术的潜在改进、可能的收购或其他公司机会、GIOSTAR自己的诊所业务、以及GIO与GIOSTAR的协议,包括GIOSTAR供应协议或其他协议、员工保留或招聘或GIO的股息政策有关的冲突。
如果对GIO的Treatments的需求低于GIO的预期,GIO从计划的Treatment产品中获得收入的能力可能会受到不利影响,GIO的业务可能不会实现,或者可能会受到影响。
GIO打算经营的市场竞争激烈,充满活力,对经济的健康状况特别敏感。经济的不确定性可能会对治疗需求产生不利影响。可能影响治疗需求的因素包括一般商业条件、就业水平、利率、税率、消费者信贷的可获得性、消费者对未来经济状况和风险的信心,或公众对与流行病或流行病(如新冠疫情)有关的风险的看法。如果经济长期低迷或严重衰退,消费者的消费习惯可能受到不利影响,这可能对GIO的业务、财务状况、经营业绩和前景产生重大不利影响。
如果GIO无法安排设计和制造能够生产其通用红细胞的生物反应器,通用红细胞业务可能不会成功。
GIO的Universal RBC业务线计划包括设计和建造一个原型生物反应器,以评估大批量生产Universal RBC的能力。在原型生物反应器的设计和建造之后,如果原型生物反应器的测试显示出生产通用红细胞的有希望的结果,GIO计划申请FDA批准其通用红细胞。据我们所知,由于设计、开发和制造这种生物反应器的高度技术性,目前不存在生产我们的通用红细胞所需的那种生物反应器。我们预计,建造一个原型生物反应器以测试大规模生产我们的通用红细胞的能力将需要大量的时间和金钱,因为原型生物反应器将是为我们的目的定制的。我们目前没有能力或资源来创建或生产我们自己的原型生物反应器,并已开始与第三方制造商就构建原型生物反应器进行初步讨论,以测试我们的通用红细胞的生产。
如果GIO最终无法开发出原型生物反应器,或者这种原型生物反应器未能成功生产出通用红细胞,这可能会对GIO的业务、财务状况、运营结果和前景产生重大不利影响,通用红细胞业务可能会彻底失败。
GIO在管理其增长和扩大业务方面可能遇到困难。
随着GIO的Treatments进入开发、商业化、临床前研究和任何临床试验阶段,GIO将需要扩大其开发、监管和制造能力,或者与其他组织签订合同,为其提供这些能力。
为了管理GIO未来的预期增长,GIO将开发管理、运营和财务系统,并招聘和培训更多合格人员。由于GIO的财政资源有限,而且在管理一家有着如此预期增长的公司方面非常复杂,GIO可能无法有效地管理其业务的扩张,或招聘和培训更多的合格人员。GIO业务的扩张可能导致巨额成本,并可能分流GIO的管理和业务发展资源。任何无法管理增长的情况都可能会延迟GIO商业计划的执行,或者扰乱我们的运营。
此外,未来的增长给管理层成员带来了重大的额外责任,包括:识别、招聘、整合、维护和激励更多员工;有效管理GIO的内部开发工作,包括GIO的Treatments的临床和FDA审查流程,同时遵守GIO对承包商和其他第三方的潜在合同义务;发展GIO的运营、财务和管理控制、报告系统和程序。
83
如果GIO在扩大业务的过程中无法满足需求,GIO在发现和开发潜在的未来疗法方面也可能遇到困难。未来,GIO还希望管理与合作者、供应商和其他组织的更多关系。GIO管理运营和未来增长的能力将要求它开发和监控控制、报告系统和程序,并确保有足够的设施满足GIO的运营需求。GIO可能无法以有效或及时的方式开发其管理信息和控制系统,并可能发现现有系统和控制的缺陷。
如果GIO的Treatments价格上涨或消费者支出减少导致销售额下降,通胀率上升可能会对GIO的收入和盈利能力产生负面影响。此外,如果GIO的成本增加,而GIO无法将这些价格上涨转嫁给客户,GIO的净利润将受到不利影响,不利影响可能是重大的。
通货膨胀率最近有所上升,特别是在美国。通胀加剧可能导致对GIO的Treatments的需求下降、运营成本(包括劳动力成本)增加、流动性减少,以及GIO获得信贷或以其他方式筹集债务和股权资本的能力受到限制。此外,美国联邦储备银行已经提高了利率,并可能再次提高利率,以回应对通货膨胀的担忧。加息,特别是如果再加上政府支出减少和金融市场波动,可能会进一步增加经济不确定性,加剧这些风险。
影响金融服务业的不利事态发展可能直接或通过对GIO未来供应商和客户的不利影响,对GIO的流动性、财务状况和经营业绩产生不利影响。
影响金融机构的不利事态发展,例如传闻中或实际发生的涉及流动性的事件,过去和将来都可能导致银行破产和/或整个市场的流动性问题。这些事件可能直接或通过对GIO未来供应商和客户的不利影响,对GIO的财务状况和经营业绩产生不利影响。例如,2023年3月10日,硅谷银行被加州金融保护和创新部关闭,后者指定联邦存款保险公司(FDIC)为接管人。同样,在2023年3月12日,Signature银行被接管。从那时起,就有报道称美国其他银行存在不稳定。尽管联邦储备委员会、财政部和联邦存款保险公司已采取措施,确保硅谷银行和Signature银行的储户能够获得其所有资金,包括无保险存款账户中的资金,并已采取额外措施,向其他银行提供流动性,但不能保证,如果将来其他银行或金融机构关闭,储户将能够获得无保险资金,或他们将能够及时获得这些资金。
迄今为止,GIO尚未因上述事件而对其流动性、财务状况或业务结果产生任何不利影响。然而,其他银行或金融机构的破产可能使GIO直接或通过对供应商、客户或其他第三方的影响而面临额外风险,并可能导致GIO的运营、财务状况和声誉受到严重干扰。此外,更广泛的金融服务业的流动性问题仍存在不确定性。GIO的业务可能会受到这些事态发展的不利影响,其方式目前无法预测,可能还会有其他风险尚未发现,它也不能保证它能够直接或间接地避免一家或多家银行或其他金融机构的任何破产所造成的负面后果。
在GIO或其所依赖的第三方拥有集中的临床试验场所或其他业务的区域,GIO的业务可能受到健康大流行病或流行病的影响,包括新冠疫情大流行病和该疾病未来的爆发。
GIO的业务可能会受到健康流行病或流行病的影响,包括新冠疫情和该疾病未来爆发的影响。例如,临床试验的注册可能会延迟。这种不确定性以及政策和限制不断变化的性质,可能会对生产率产生负面影响,扰乱GIO的未来业务。
在全球范围内造成广泛影响的新冠疫情的蔓延,可能会在经济上影响GIO。虽然新冠疫情带来的潜在经济影响和持续时间可能难以评估或预测,但它已造成全球金融市场的严重混乱。这种中断如果持续或经常发生,可能会使GIO更难获得资金,这可能在未来对其流动性产生负面影响。此外,新冠疫情蔓延导致的经济衰退或市场调整可能会对GIO的业务及其普通股价值产生重大影响。全球新冠疫情大流行病继续演变,其最终影响或任何类似的卫生大流行病或流行病的最终影响是高度不确定的。GIO尚不清楚潜在的延迟或对其未来业务的影响的全部程度。
84
与发现、开发、制造和商业化有关的风险
如果GIO不能及时或根本不能完成其部分或全部治疗的开发、获得适用的监管批准和商业化,其业务将受到损害。
GIO未来的成功在一定程度上取决于它能否及时推进和完成适用的临床试验,获得其Treatments的上市许可,并成功地将其商业化。在获得FDA和类似的外国监管机构的营销批准之前,GIO不得营销或推广其某些疗法,GIO可能永远不会获得此类营销批准。
GIO的Treatments能否成功将取决于以下几个因素:
| ● | 临床研究人员将患者置于临床试验中的意愿,以及患者参加研究治疗的临床试验的意愿; |
| ● | 在美国和国际上获得并维持专利保护、商业秘密保护和监管排他性; |
| ● | 在获得任何营销批准后,继续保持可接受的安全状况; |
| ● | 患者、医学界和第三方支付方的商业接受; |
| ● | GIO与其他Treatments竞争的能力。 |
GIO不能完全控制其中许多因素,包括临床开发和监管提交过程的某些方面、对其知识产权的潜在威胁以及任何未来合作者的制造、营销、分销和销售努力。如果GIO不能及时或根本不能在这些因素中的一个或多个方面取得成功,它可能会遇到重大延误或无法成功地将其治疗商业化,这将对其业务造成重大损害。
如果GIO的任何疗法导致严重的不良事件、不良副作用或意外特征,这些事件、副作用或特征可能会延迟或阻止监管机构批准此类疗法或其未来开发的其他疗法,导致负面新闻报道,限制其商业潜力,或对GIO及其前景造成其他重大负面后果。
GIO’s Treatments引起的不良副作用或不良事件可能导致GIO或监管机构中断、延迟或停止临床试验或操作,可能导致对Treatments的更严格的标签,延迟或导致FDA或类似的外国监管机构拒绝监管批准。GIO的Treatments临床试验结果可能揭示出严重程度高且不可接受的副作用和普遍程度,或意想不到的特征。与治疗相关的副作用也可能影响患者招募或入组患者完成试验的能力,或导致潜在的产品责任索赔。
如果GIO开发的任何治疗与严重不良事件、不良副作用或意外特征相关,可能需要放弃其开发或将开发限制在某些用途或亚群中,在这些用途或亚群中,严重不良事件、不良副作用或其他特征不那么普遍、不那么严重或从风险收益的角度来看更容易被接受,其中任何一种都会对GIO的业务、财务状况、运营结果和前景产生重大不利影响。许多最初在早期测试中显示出前景的治疗方法后来被发现会引起副作用,阻碍治疗的进一步临床发展。
临床前研究和早期临床试验的结果可能不能预测未来临床试验的结果,这些结果并不能保证管理当局批准治疗。
临床前研究和早期临床试验的结果可能不能预测后期临床试验的成功,临床试验的中期结果也不一定能预测已完成临床试验的结果是否成功。不能保证GIO未来的任何临床前和临床试验(与其治疗相关)最终会成功,或支持进一步的临床前或临床开发。制药和生物技术行业的许多公司在早期开发中取得积极成果后,在后期临床试验中遭受了重大挫折,GIO也可能面临类似的挫折。设计一个
85
临床试验可以决定其结果是否支持产品的批准,在临床试验进展顺利之前,临床试验设计中的缺陷可能不会变得明显。许多公司认为他们的疗法在临床前研究和临床试验中表现令人满意,但他们的疗法未能获得监管机构的批准。此外,临床前和临床数据往往容易受到不同解释和分析的影响,这可能会延迟、限制或阻止监管机构的批准。此外,由于许多因素,包括产品开发期间监管政策的变化,可能会遇到监管方面的拖延或拒绝。任何此类不良事件都可能导致GIO推迟、限制或终止计划中的临床试验,其中任何一项都将对GIO的业务、财务状况、运营结果和前景产生重大不利影响。
在某些情况下,由于多种因素,包括方案中规定的试验程序的变化、患者群体的规模和类型的差异、给药方案和其他临床试验程序的变化和依从性以及临床试验参与者的退出率,同一治疗方案的不同临床试验之间的安全性或有效性结果可能存在显着差异。如果GIO未能在其Treatments的临床试验中获得积极的结果,其最先进的Treatment的开发时间表、监管批准和商业化前景,相应地,其业务和财务前景将受到负面影响。
如果GIO在未来任何临床试验中的患者登记方面遇到延迟或困难,开发Treatments的成本可能会增加,其获得必要的监管批准可能会被延迟或阻止。
患者入组是临床试验时间安排的一个重要因素。GIO未来临床试验的时间安排,在一定程度上取决于GIO招募患者参与其试验的速度。如果GIO无法按照FDA、EMA或美国以外的其他类似监管机构的要求,找到并招募足够数量的合格患者参加这些试验,或者为特定试验提供适当的统计能力,GIO或其合作者可能无法开始GIO确定或开发的任何治疗的临床试验。患者可能不愿意参加GIO的临床试验,因为与生物技术、基因疗法或基因组工程领域相关的不良事件、针对类似患者群体的竞争性临床试验、竞争性疗法的临床试验或其他原因的负面宣传。因此,招募患者、进行试验和获得Treatments监管批准的时间表被推迟。
患者入组也受到其他因素的影响,包括:
| ● | 患者群体的规模和识别患者的过程; |
| ● | 审判程序的设计; |
| ● | 获得和保持患者知情同意的能力; |
| ● | 入组患者在试验完成前退出的风险; |
| ● | 有关审判的资格和排除标准; |
| ● | 试验中的治疗的风险和益处; |
| ● | 认为干细胞疗法作为一种治疗方法的风险和益处; |
| ● | 努力促进临床试验的及时注册; |
| ● | 病人转诊做法; |
| ● | 在治疗期间和治疗后对病人进行充分监测的能力; |
| ● | 对未来患者,特别是对那些患者人数较少的病症而言,临床试验地点的临近程度和可得性; |
| ● | 在专门从事这一程序的中心进行人体干细胞移植的要求;以及 |
86
| ● | 对诊断技术、方法或用于识别人类干细胞转移患者复发高风险的标准的改变。 |
此外,GIO开展的任何临床试验都将与与GIO的Treatments处于相同领域的其他Treatments临床试验展开竞争,这种竞争将减少可用的患者数量和类型,因为一些选择参加GIO试验的患者可能会选择参加竞争对手正在进行的试验。GIO可能会在某些竞争对手使用的相同临床试验地点进行某些临床试验,这将减少可在此类临床试验地点进行其临床试验的患者人数。
GIO临床试验的注册延迟可能导致GIO可能开发的任何疗法的开发成本增加,这将导致GIO的价值下降,并限制GIO获得额外融资的能力。如果GIO或其合作者难以招募足够数量的患者按计划进行临床试验,GIO可能需要推迟、限制或终止正在进行或计划进行的临床试验,其中任何一项都将对GIO的业务、财务状况、运营结果和前景产生不利影响。
GIO从未获得过治疗的监管批准,可能永远不会获得任何治疗的监管批准,因此可能永远不会从产品销售中获得收入。
作为一家公司,GIO从未获得任何产品的监管批准或商业化。FDA或其他监管机构可能拒绝接受任何或所有未来的Treatments进行实质性审查,或者在审查了GIO的数据后得出结论,认为其申请不足以获得Treatments的监管批准。如果FDA或其他监管机构不批准任何未来的治疗方案,它可能会要求GIO在FDA或其他监管机构重新考虑GIO的申请之前,进行额外的昂贵的临床、临床前或制造验证研究。根据这些或任何其他FDA要求或其他监管机构要求的研究的程度,GIO提交的任何治疗或其他申请的批准可能会大大延迟,可能会持续数年,或者可能需要花费比现有资源更多的资源。在获得监管批准方面的任何失败或延迟都将阻止GIO将任何治疗商业化,产生收入并实现和获得或维持盈利能力。还有一种可能是,如果进行和完成了更多的研究,FDA或其他监管机构可能认为这些研究不足以批准GIO提交的任何新产品申请或其他申请。如果出现上述任何结果,GIO可能会被迫放弃其Treatments的开发,这将对GIO的业务产生重大不利影响,并可能导致GIO停止运营。GIO在外国司法管辖区的应用也面临着类似的风险。
如果我们不能教育临床医生安全、有效和适当地使用我们的治疗和程序,我们可能会遇到更多的产品责任索赔,可能无法实现我们的预期增长。
我们的某些治疗需要使用专门的技术和/或产品特定的知识。对我们业务的成功至关重要的是,要广泛地教育那些将使用或希望使用我们的治疗方法的临床医生,以便向他们提供适当使用我们的治疗方法的适当指导。同样重要的是,我们教育我们的其他客户和患者与我们的治疗相关的风险。未能提供足够的培训和教育可能导致(其中包括)不满意的患者结果、患者受伤、负面宣传或增加针对我们的产品责任索赔或诉讼,其中任何一项都可能对我们的业务和声誉产生重大不利影响。我们将向临床医生和我们的其他客户提供广泛的教育资源,以确保他们能够获得当前的治疗方法,了解我们治疗的优势和风险,并接受有关安全和适当使用我们治疗的教育。然而,无法保证这些资源将成功地防止所有负面事件,如果我们未能教育临床医生、我们的其他客户和患者,他们可能会在不完全了解风险和益处的情况下就我们的治疗做出决定或形成结论,或者可能对我们的治疗持负面看法。此外,即使此类索赔没有依据和/或不存在产品缺陷,也可能会发生针对我们的索赔,原因是,例如,不适当的手术技术、不适当地使用我们的治疗方法,或对安全和有效地使用我们的治疗方法缺乏其他意识。任何这些事件都可能损害我们的业务和业务结果。
GIO的商业成功有赖于其Treatments(如果获得批准)在患者、客户、诊所运营商以及(在某些情况下)化妆品和涉及抗衰老产品的公司中获得巨大的市场认可,而GIO可能无法成功获得这种市场认可。
即使获得了美国FDA、欧盟EMA和其他国际监管机构的必要批准,GIO的一些治疗的商业成功将在一定程度上取决于其市场接受程度。
87
患者、第三方支付者和医学界的其他人。GIO商业化的任何产品都可能无法获得患者、医疗保健支付者和医学界其他人的认可。如果这些治疗方法没有达到足够的接受程度,GIO可能不会产生可观的产品收入,也可能无法盈利。向医学界和第三方支付者宣传其治疗的益处的努力可能需要大量资源,包括管理时间和财政资源,而且可能不会成功。有关治疗和干细胞技术的伦理、社会和法律方面的担忧,可能会导致更多的法规限制或禁止GIO的治疗的营销。即使开发的任何治疗GIO获得了市场批准,它也可能无法获得患者、医疗支付者和医学界其他人的充分市场认可。如果批准商业销售,市场对任何治疗GIO开发项目的接受程度将取决于若干因素,包括:
| ● | 临床试验证明的这种治疗的有效性和安全性; |
| ● | 与GIO的疗法联合使用或顺序使用的其他疗法的有效性和安全性; |
| ● | 与替代疗法相比,GIO’s Treatments的潜在优势和感知优势; |
| ● | 对GIO目标患者群体的限制以及FDA或其他监管机构批准的标签中包含的限制或警告; |
| ● | 有能力以有竞争力的价格出售GIO’s Treatments; |
| ● | 与替代疗法相比,给药的便利性和便利性; |
| ● | 经FDA、EMA或其他监管机构批准治疗的临床适应症; |
| ● | 公众对干细胞的态度; |
| ● | 目标患者群体尝试新的生物制剂治疗的意愿; |
| ● | FDA、EMA或其他监管机构的产品标签或产品说明书要求,包括产品批准标签中包含的任何限制或警告; |
| ● | 相对方便和易于管理或使用; |
| ● | 营销和分销支持的力度; |
| ● | 第三方覆盖范围的提供和偿还的充分程度;以及 |
| ● | 任何副作用的普遍程度和严重程度。 |
即使一种治疗方案获得批准,这种产品也可能达不到足够的接受程度,GIO可能不会产生可观的产品收入,GIO也可能无法盈利。
如果GIO无法建立有效的营销和销售能力,或无法与第三方签订协议来营销和销售其Treatments(如果获得批准),GIO可能无法有效营销和销售其Treatments(如果获得批准),或产生产品收入。
GIO的营销能力有限,在药品或生物治疗的销售、营销或分销方面经验有限。此外,GIO没有很大的销售、推广和营销预算。由于GIO的营销能力有限,要让GIO保留销售和营销职责的任何产品获得商业成功,它必须要么建立一个销售和营销组织,要么将这些职能外包给第三方。未来,GIO可能会选择建立一个重点突出的销售、营销和商业支持基础设施,以便在GIO的某些Treatments获得批准后,与其合作者一起销售或参与销售活动。
88
可能阻碍GIO自行将其Treatments商业化的因素包括:
| ● | GIO无法征聘和保留足够数量的有效销售、营销、报销、客户服务、医疗事务和其他支助人员; |
| ● | 偿还专业人员无法就付款人获取、偿还和以其他方式接受明文规定的安排进行谈判; |
| ● | 分销渠道受限或封闭,难以将GIO的Treatments分销给患者群体; |
| ● | 销售人员缺乏可提供的补充性治疗,这可能使GIO相对于拥有更广泛产品线的公司处于竞争劣势;以及 |
| ● | 与创建一个独立的商业化组织有关的意外费用和开支。 |
GIO可能无法成功地与第三方达成将其治疗商业化的安排,或者可能无法以对其有利的条件这样做。GIO可能对这些第三方几乎没有控制权,而且其中任何一方都可能没有投入必要的资源和注意力来有效地销售和营销其Treatments。如果GIO不能成功地建立商业化能力,无论是自己还是与第三方合作,它就不能成功地将其Treatments商业化。
在技术快速变化的环境中,GIO可能面临重大竞争,其竞争对手可能会先于GIO获得监管批准,或开发出比GIO更安全、更先进或更有效的Treatments,这可能会损害GIO的财务状况及其成功营销或商业化其Treatments的能力。
新生物疗法的开发和商业化具有很强的竞争力。GIO未来开发或商业化的任何疗法都将面临来自世界各地主要制药公司、专业制药公司和生物技术公司的竞争。潜在的竞争者还包括学术机构、政府机构和其他进行研究、寻求专利保护和为研究、开发、制造和商业化建立合作安排的公共和私营研究组织。
有许多大大小小的制药和生物技术公司目前正在营销和销售Treatments,或者正在为GIO拥有Treatments和研究项目的治疗开发Treatments。其中一些竞争性治疗和疗法基于与GIO的方法相同或相似的科学方法,另一些则基于完全不同的方法。GIO成功开发和商业化的任何疗法将与现有疗法、新疗法和未来可能出现的疗法竞争,这些疗法被批准用于治疗GIO可能获得其疗法批准的相同病症或用于相同目的。
与GIO相比,GIO目前或潜在的许多竞争对手,无论是单独竞争,还是与合作伙伴合作,在研发、制造、临床前测试、开展临床试验、获得监管批准和上市批准治疗方面的财力和专业知识,可能都要多得多。制药和生物技术行业的并购可能导致更多的资源集中在GIO数量较少的竞争对手手中。较小或处于早期阶段的公司也可能被证明是重要的竞争对手,特别是通过与大型和成熟公司的合作安排。这些竞争对手还在招募和留住合格的科学和管理人员、建立临床试验场所和临床试验的患者登记,以及获取与GIO项目互补或必要的技术方面与GIO展开竞争。如果GIO的竞争对手开发和商业化比GIO的Treatments更安全、更有效、副作用更少或更轻、更方便或更便宜的Treatments,或者导致GIO的Treatments过时或失去竞争力,那么GIO的商业机会可能会减少或消失。GIO的竞争对手也可能比GIO更快地获得FDA或其他监管机构的批准,这可能导致其竞争对手在GIO进入市场之前就建立起强大的市场地位。此外,GIO的竞争对手开发的技术可能会使GIO的Treatments变得不经济或过时,GIO可能无法成功地向竞争对手推销任何Treatments。
89
公众对干细胞疗法的负面看法可能会对GIO潜在疗法的监管批准和/或需求产生负面影响。
他们可能开发的GIO疗法将利用人类干细胞来创造。GIO的潜在疗法能否在临床和商业上取得成功,在一定程度上将取决于公众对干细胞疗法和疗法用于预防或治疗人类疾病或创造疗法的理解和接受程度。公众的态度可能会受到干细胞疗法不安全、不道德或不道德的说法的影响,因此,GIO的疗法可能无法获得公众或医学界的认可。公众的负面态度可能会对GIO注册临床试验的能力产生不利影响
此外,由于与将干细胞疗法应用于人类胚胎有关的伦理问题,干细胞疗法受到公众辩论和加强监管审查。GIO的临床前研究或未来临床试验中的不良事件,或其竞争对手或利用这些技术的学术研究人员的不良事件,即使最终不能归因于GIO可能识别和开发的疗法,伴随而来的宣传可能会导致政府监管的加强、公众的负面看法、GIO可能识别和开发的疗法的测试或批准的潜在监管延迟、对那些已获批准的疗法的更严格的标签要求以及对任何此类疗法的需求下降。
GIO的成功在很大程度上取决于消费者对GIO的Treatments的有效性是否满意。
为了产生重复和转诊业务,消费者必须对GIO的Treatments的有效性感到满意。GIO的一些治疗方法本质上是美化的,结果的成功是高度主观的。因此,即使GIO的治疗和相关程序在客观上是成功的,患者对其结果的看法也可能存在很大差异。如果消费者对GIO的Treatments的好处不满意,或者觉得它们的价格太高,无法获得结果,那么GIO的声誉和未来的销售可能会受到影响。
任何有关GIO Treatments的负面报道都可能损害GIO的业务和声誉,并对GIO的财务业绩产生负面影响。
潜在客户、新闻媒体、立法和监管机构以及其他人对GIO治疗并发症或所谓并发症信息的反应可能会导致负面宣传,并可能大幅降低市场对GIO治疗的接受度。这些反应,或任何调查以及由此产生的潜在负面宣传,可能对GIO的业务和声誉产生重大不利影响,并对GIO的财务状况、经营业绩或合并后公司普通股的市场价格产生负面影响。此外,重大的负面宣传可能导致针对GIO的产品责任索赔数量增加。
如果针对GIO提起产品责任诉讼,GIO可能会承担重大责任,并可能被要求限制其Treatments的商业化。
GIO面临与其Treatments的人体临床试验相关的产品责任暴露的固有风险,如果GIO将其可能开发的任何Treatments商业化销售,将面临更大的风险。例如,如果GIO的治疗方案在临床试验、制造、营销或销售过程中造成或被认为造成伤害或被发现在其他方面不合适,GIO可能会被起诉。任何此类产品责任索赔可包括对制造缺陷、设计缺陷、未就处理中固有的危险发出警告、疏忽、严格责任或违反保证的指控。也可以根据国家消费者保护法提出索赔。如果GIO不能成功地针对其Treatments造成伤害的指控进行抗辩,GIO可能会承担重大责任,或被要求限制其Treatments的商业化。即使是成功的防御也需要大量的财政和管理资源。不论案情或最终结果如何,赔偿责任索赔可能导致:
| ● | 无法将GIO可能开发的任何Treatments商业化; |
| ● | 对GIO可能开发的Treatments的需求下降; |
| ● | 损害GIO的声誉和重大的负面媒体关注; |
| ● | 任何未来临床试验参与者的退出; |
| ● | 为相关诉讼进行辩护所需的大量时间和费用; |
90
| ● | 向试验参与者或患者提供大量金钱奖励;以及 |
| ● | 收入损失。 |
尽管GIO计划获得产品责任保险,但它可能不足以涵盖它可能产生的所有责任。GIO预计,随着GIO开始临床试验,如果GIO成功地将任何疗法商业化,它将需要增加其保险范围。保险范围越来越昂贵。GIO可能无法以合理的成本或足以支付可能产生的任何赔偿责任的金额维持保险范围。
如果对GIO的Treatments或GIO的Treatments提供的服务没有足够的需求,医生对GIO的Treatments的需求可能会下降,从而导致不利的经营业绩。
扩大GIO的Treatments市场是GIO商业战略的一个重要假设。大多数计划使用GIO服务执行的程序都是选择性程序,因此不能通过政府或私人医疗保险报销,因此费用必须由消费者承担。因此,使用GIO服务的决定可能受到若干因素的影响,包括:
| ● | 医生采用GIO的干细胞疗法。 |
| ● | 使用GIO’s Treatments进行手术的成本; |
| ● | 替代疗法的成本、安全性和有效性; |
| ● | GIO销售和营销工作的成功; |
| ● | 对GIO的客户及其患者进行教育,让他们了解GIO的Treatments与竞争对手的Treatments和技术相比的益处和用途; |
| ● | 消费者可支配收入和获得消费信贷的机会;以及 |
| ● | 消费者信心,这可能受到经济和政治状况的影响。 |
如果由于这些因素,对我们治疗的需求不足,医生对GIO治疗的需求可能会下降,这将导致消费者程序减少,并可能对我们的手术结果产生重大不利影响。
GIO的Treatments很复杂,很难制造。GIO可能会在满足监管当局要求方面遇到延误,或出现生产问题,从而导致其开发或商业化计划的延误,限制其Treatments的供应,或以其他方式损害其业务。
GIO的治疗需要极其复杂的处理步骤。其结果是,制造过程中的问题,甚至是与正常过程的微小偏差,都可能导致产品缺陷或制造失败,从而导致批次故障、产品召回、产品责任索赔、库存不足,或可能延迟GIO临床试验的进展。如果GIO成功开发Treatments,它可能会遇到以下问题:在满足FDA、EMA或其他可比较的适用国外标准或规范的足够数量和质量的临床级别材料方面,以及在生产产量和成本方面一致和可接受的问题。此外,GIO的Treatments将需要复杂的递送方式,例如电穿孔,这将在制造过程中引入额外的复杂性。
除其他外,制造人类干细胞包括从捐献者或患者身上采集细胞,利用技术对细胞进行体外改造,将细胞产物注入患者体内,或在实验室中扩充干细胞。GIO的制造过程很容易受到产品丢失或失败的影响,或者产品变化可能会对患者的治疗效果产生负面影响,原因包括:从供体收集起始材料、准备给药的产品、向患者注入治疗药物等相关的后勤问题、制造问题或由于供体起始材料的差异、试剂批次之间的差异、制造过程中的中断、污染、设备或试剂失效、设备安装或操作不当、供应商或操作人员的失误、细胞生长的不一致以及产品特性的可变性而导致的不同产品特性。与其他许多干细胞公司一样,GIO的制造过程也将被描述为
91
由数量有限的供应商,在某些情况下是唯一的来源供应商,具有制造能力和专门知识来创造或采购材料。虽然GIO计划为其制造过程的关键部件寻找多个来源,但它可能根本无法或无法及时获得这些额外来源。如果在GIO的Treatments或制造Treatments或其他材料的任何制造设施中发现微生物、病毒或其他污染,这些制造设施可能需要长时间关闭,以调查和补救污染。
此外,FDA、EMA和其他监管机构可能会要求GIO在任何时候提交任何批批准产品的样品以及显示适用测试结果的协议。在某些情况下,FDA、EMA或其他监管机构可能会要求GIO在该机构授权发布之前不能大量分发。制造过程中的轻微偏差,包括那些影响质量属性和稳定性的偏差,可能会导致产品出现不可接受的变化,从而导致批次故障或产品召回。批次故障或产品召回可能导致GIO推迟临床试验或产品发布,这可能会给GIO带来代价,并以其他方式损害其业务、财务状况、运营结果和前景。
GIO预计其制造过程中需要的一些原材料来自生物来源。这种原材料很难获得,可能会受到污染或被召回。材料短缺、污染、召回或限制在GIO的Treatments制造中使用生物衍生物质,可能会对临床材料的商业制造或生产产生不利影响或中断,这可能对GIO的开发时间表及其业务、财务状况、运营结果和前景造成重大损害。
如果GIO或其聘用的任何合同研究组织、合同制造商或供应商不遵守环境、健康和安全法律法规,GIO可能会受到罚款或处罚,或产生可能对其业务成功产生重大不利影响的费用。
GIO及其参与的任何合同研究组织、合同制造商和供应商都必须遵守许多联邦、州和地方环境、健康和安全法律、法规和许可要求,包括有关实验室程序的规定;危险和受管制材料和废物的生成、处理、使用、储存、处理和处置;向地下、空气和水中排放和排放危险材料;以及员工的健康和安全。GIO的业务可能涉及使用危险和易燃材料,包括化学品以及生物和放射性材料。GIO的业务也可能产生危险废物。GIO计划与第三方签订处置这些材料和废物的合同。尽管GIO相信,其和此类第三方处理、储存和处置这些材料和废物的程序将符合法律规定的标准,但GIO无法消除这些材料造成污染或伤害的风险。如果GIO使用危险材料造成污染或伤害,GIO可能对由此造成的任何损害承担责任,而且任何责任都可能超出其资源范围。根据某些环境法,GIO可对其现有或过去设施以及第三方设施的任何污染所涉费用负责。GIO还可能产生与民事或刑事罚款和处罚相关的巨额成本。
遵守适用的环境法律和法规可能代价高昂,当前或未来的环境法律和法规可能会损害GIO的产品开发和研究工作。此外,GIO不能完全消除这些材料或废物造成意外伤害或污染的风险。尽管GIO计划维持工人赔偿保险,以支付GIO因雇员因使用危险材料而受伤而可能产生的成本和费用,但这种保险可能无法充分覆盖潜在的责任。GIO不承保特定的生物或危险废物保险,GIO将获得的财产、伤亡和一般责任保险可能特别不包括因生物或危险废物暴露或污染而造成的损害和罚款。因此,如果发生污染或伤害,GIO可能被追究损害赔偿责任,或被处以超出其资源的罚款,GIO的临床试验或监管批准可能被暂停,这可能对其业务、财务状况、运营结果和前景产生重大不利影响。
此外,为了遵守当前或未来的环境、健康和安全法律、法规和许可要求,GIO可能会产生大量费用。这些当前或未来的法律、法规和许可要求可能会损害GIO的研发或生产努力。不遵守这些法律、法规和许可要求还可能导致巨额罚款、处罚或其他制裁或业务中断,这可能对GIO的业务、财务状况、经营业绩和前景产生重大不利影响。
GIO从事的任何第三方合同研究组织、合同制造商和供应商也将受这些以及其他环境、健康和安全法律和法规的约束。他们根据这些法律和条例所承担的责任可以
92
导致巨额成本或运营中断,这可能对GIO的业务、财务状况、运营结果和前景产生重大不利影响。
与监管审查有关的风险
如果GIO的Treatments未来的任何临床试验未能证明其安全性和有效性,令监管机构满意,或者没有产生积极的结果,GIO可能会在完成或最终无法完成此类Treatments的开发和商业化方面产生额外成本或经历延迟。
在获得监管部门批准销售GIO识别和开发的任何疗法之前,GIO必须完成临床前开发,然后进行广泛的临床试验,以证明此类疗法在人体中的安全性和有效性。临床测试费用昂贵,难以设计和实施,可能需要很多年才能完成,结果也不确定。一项或多项临床试验的失败可能发生在试验的任何阶段。临床前试验和早期临床试验的结果不一定能预测后期临床试验的成功,临床试验的中期结果也不一定能预测最终结果。此外,临床前和临床数据往往容易受到不同解释和分析的影响。许多公司认为,他们的疗法在临床前研究和临床试验中表现令人满意,但仍未能获得其疗法的上市许可。
| ● | GIO及其合作者(如果有的话)可能在临床试验期间或由于临床试验而经历许多不可预见的事件,这些事件可能会延迟或阻止GIO获得营销批准或将任何治疗商业化的能力,包括: |
| ● | 迟迟未能与监管机构就试验设计达成共识; |
| ● | 监管机构、内部审查委员会、独立伦理委员会或科学审查委员会不得授权GIO或其调查人员在预期的试验地点开始临床试验或进行临床试验; |
| ● | 与预期的CRO和临床试验地点就可接受的临床试验合同或临床试验方案达成或未能达成协议的延误; |
| ● | Treatments的临床试验可能产生负面或不确定的结果,GIO可能决定或监管机构可能要求其进行额外的临床试验或放弃产品开发或研究计划; |
| ● | 由于伦理方面的考虑,在设计良好对照的临床试验时遇到困难,这可能导致不宜使用可以有效地与治疗组进行比较的对照组进行试验; |
| ● | 难以设计临床试验和选择未得到充分研究和对疾病的自然历史和病程了解不多的疾病的终点; |
| ● | 临床试验所需的患者人数可能比预期的要多;在这些临床试验中招募合适的参与者的时间可能比预期的要晚或慢;或者患者退出这些临床试验的速度可能比GIO预期的要高; |
| ● | GIO的第三方承包商可能未能及时遵守监管要求或履行其对GIO的合同义务,或根本不履行; |
| ● | 监管机构、IRB或独立伦理委员会可能会要求GIO或其调查人员出于各种原因暂停或终止临床研究或临床试验,包括不遵守监管要求、发现不良副作用或其他意外特征,或参与者面临不可接受的健康风险,或在对GIO的临床试验操作或试验地点进行检查后; |
| ● | 临床试验的成本可能高于GIO的预期; |
| ● | 进行临床试验所需的Treatments或其他材料的供应或质量可能不足或不足,包括由于GIO或与GIO签订合同履行其中某些职能的第三方在测试、验证、制造和向临床地点交付Treatments方面的延误; |
93
| ● | 延误病人完全参加试验或返回治疗后随访; |
| ● | 退出试验的临床试验地点; |
| ● | 选择需要长时间临床观察或分析结果数据的临床终点; |
| ● | 与治疗相关的严重不良事件的发生,这些事件被认为超过了其潜在的益处; |
| ● | 在由其他赞助商进行的同类药物试验中发生严重不良事件;以及 |
| ● | 需要修改或提交新的临床方案的监管要求和指导的变化。 |
如果GIO或其合作者(如果有的话)被要求对Treatments进行超出GIO目前考虑范围的额外临床试验或其他测试,如果GIO或其合作者无法成功完成Treatments的临床试验或其他测试,或者如果这些试验或测试的结果不是阳性或仅是轻微阳性,或者如果存在安全问题,GIO或其合作者可以:
| ● | 延迟获得任何此类治疗的上市批准或根本没有获得上市批准; |
| ● | 获得适应症或患者群体的批准,而这些适应症或患者群体的范围没有达到预期或期望的那么广; |
| ● | 获得包括重要使用或分配限制或安全警告的标签的批准,包括黑框警告; |
| ● | 受产品给药方式变化的影响; |
| ● | 被要求进行额外的临床试验以支持批准或接受额外的上市后测试要求; |
| ● | 是否有监管当局撤销或暂停批准该产品,或以风险评估和缓解战略(“REMS”)或通过修改现有REMS的形式对其销售施加限制; |
| ● | 被起诉;或 |
| ● | GIO的声誉受到了损害。 |
如果GIO或其合作者在临床试验或其他测试或获得营销批准方面遇到延误,产品开发成本也将增加。GIO不知道任何临床试验是否会按计划开始,是否需要重组,是否会如期完成,或者根本不知道。重大的临床试验延迟也可能缩短GIO拥有Treatments商业化独家权利的时间,可能让其竞争对手在GIO之前将Treatments推向市场,并可能损害GIO成功将Treatments商业化的能力,其中任何一项都可能损害GIO的业务、财务状况、运营结果和前景。
此外,FDA和其他机构的中断可能会延长新产品获得必要的政府机构审查和/或批准的时间,这将对GIO的业务产生不利影响。例如,在过去几年里,美国政府多次关闭,包括FDA在内的某些监管机构不得不让关键员工休假,并停止关键活动。如果政府长期关闭,可能会严重影响FDA及时审查和处理GIO提交的监管文件的能力,这可能对其业务产生重大不利影响。
如果不能在外国司法管辖区获得营销批准,GIO开发的任何Treatments都将无法在这些司法管辖区进行营销,这反过来将严重损害GIO的创收能力。
为了营销和销售GIO在欧盟和许多其他外国司法管辖区开发的任何疗法,GIO或其合作者必须获得单独的营销批准,并遵守众多不同的监管要求。各国的批准程序各不相同,可能涉及额外的测试。获得批准所需的时间可能相差很大。
94
从获得FDA批准所需的。美国以外的监管审批程序通常包括与获得FDA批准相关的所有风险。此外,在美国以外的许多国家,必须先批准产品偿还,然后才能批准产品在该国销售。GIO或其合作者可能根本无法及时获得美国以外监管当局的批准。FDA的批准并不能确保其他国家或司法管辖区的监管当局的批准,美国以外的一个监管当局的批准也不能确保其他国家或司法管辖区的监管当局或FDA的批准。GIO可能无法申请营销批准,也可能得不到必要的批准,无法在任何法域将其治疗商业化,这将严重损害其创收能力。
此外,由于联合王国最近于2020年12月31日退出欧盟(通常被称为英国退欧),GIO在寻求在英国获得营销批准方面可能面临更大风险。根据联合王国与欧洲联盟商定的正式退出安排,联合王国退出欧洲联盟,自2020年12月31日起生效。2020年12月24日,英国和欧盟签署了一项贸易与合作协定。该协议规定了在每个司法管辖区批准和承认医疗待遇的某些程序。
由于英国的药物治疗监管框架涵盖药物或生物治疗的质量、安全和功效、临床试验、上市许可、商业销售以及药物和生物治疗的分销,这些都源自欧盟的指令和法规,英国退欧可能会对适用于治疗和治疗在英国的批准的未来监管制度产生重大影响。由于英国退欧或其他原因,在获得或无法获得任何营销批准方面的任何延迟,都将阻止GIO在联合王国和/或欧洲联盟将任何治疗商业化,并限制其创收和实现并维持盈利的能力。如果出现上述任何结果,GIO可能会被迫限制或延迟在联合王国和/或欧洲联盟寻求监管机构批准任何治疗的努力,这可能会对其业务造成重大和实质性损害。
即使GIO完成了任何未来的临床试验,它也无法预测何时或是否会获得监管机构的批准,以便在美国或任何其他司法管辖区将其疗法商业化,而且任何此类批准可能针对的是比GIO寻求的范围更窄的适应症。
在适当的管理当局审查和批准候选产品之前,GIO不能将治疗商业化。即使GIO的Treatments在临床试验中达到其安全性和有效性终点,监管机构也可能无法及时完成其审查过程,或者GIO可能无法获得监管批准。如果FDA咨询委员会或其他监管机构建议不批准或限制批准,可能会导致额外的延迟。此外,在产品开发、临床试验和审评过程期间,由于政府对未来立法或行政行动的额外监管,或监管当局政策的变化,GIO可能会遇到延误或拒绝。
管理当局也可以批准一种治疗,其适应症比要求的更有限,也可以以狭窄的适应症、警告或REMS的形式施加重大限制。这些管理当局可要求在标签上列入与使用条件有关的预防措施或禁药指示,或可根据昂贵的上市后临床试验的执行情况批准。此外,监管机构可能不会批准GIO的Treatments成功商业化所必需或可取的标签声明。上述任何一种情况都可能严重损害GIO Treatments的商业前景,并对GIO的业务、财务状况、经营业绩和前景产生重大不利影响。
如果获得FDA在美国的上市许可,并不能确保获得其他国家或司法管辖区的监管机构的批准。此外,在一个国家进行的临床试验可能不被其他国家的管理当局接受,在一个国家的管理批准并不保证在任何其他国家的管理批准。各国的批准程序各不相同,可能涉及额外的治疗测试和验证以及额外的行政审查期。寻求外国监管机构的批准可能会给GIO带来困难和成本,并需要额外的临床前研究或临床试验,这可能是昂贵和耗时的。各国的监管要求可能差异很大,可能会推迟或阻止GIO开发的Treatments在这些国家推出。外国监管批准程序涉及与FDA批准相关的所有风险。GIO没有批准在任何司法管辖区(包括国际市场)销售任何治疗,GIO也没有在国际市场获得监管批准的经验。如果GIO未能遵守国际市场的监管要求,或未能获得并维持所需的批准,或国际市场的监管批准被推迟,GIO的目标市场将被削弱,其充分发挥Treatments市场潜力的能力将无法实现。
95
即使GIO获得监管机构对其任何疗法的批准,批准的疗法也可能需要接受批准后的研究,并将继续遵守现行的监管要求。如果GIO未能遵守规定,或者在随后的研究中发现了担忧,GIO的批准可能会被撤销,其产品销售可能会被暂停。
如果GIO的任何一种疗法成功获得监管机构的批准,美国和将销售产品的其他国家的监管机构可能需要大量额外的临床试验或批准后的临床试验,这些试验既昂贵又耗时。这些研究进行起来可能既昂贵又耗时,而且可能会揭示GIO的Treatments上市后使用患者的副作用或其他有害影响,这可能会导致GIO的产品受到限制或退出市场。或者,GIO可能无法进行此类额外试验,这可能会迫使GIO放弃开发某些疗法或将其商业化的努力。即使没有要求或要求进行批准后研究,在GIO的Treatments获得批准并上市后,随着时间的推移,可能会出现安全问题,需要改变产品标签、增加上市后研究或临床试验、在REMS下实施分销和使用限制或退出市场,这将导致GIO的收入下降。
此外,GIO可能成功开发的任何疗法在获得批准后都将受到持续监管要求的约束。这些要求将管理GIO的Treatments的制造、包装、营销、分销和使用。如果GIO未能遵守此类监管要求,其治疗方案的批准可能会被撤销,产品销售可能会被暂停。GIO可能无法恢复合规,或者GIO可能只能在长时间的拖延、巨额费用、收入损失和声誉受损后才能恢复合规。
GIO Treatments的监管环境尚不确定;与更成熟的干细胞疗法相关的法规仍在制定中,监管要求的变化可能会导致GIO Treatments的开发延迟或停止,或导致获得监管批准的意外成本。FDA和其他管理机构可能不同意GIO的监管计划,也可能无法获得GIO Treatments的监管批准。
由于GIO的Treatments和技术平台涉及干细胞,GIO面临着其他干细胞疗法面临的许多挑战和风险,包括:
| ● | 有关干细胞治疗要求的监管要求或指南已经改变,将来可能继续改变; |
| ● | 迄今为止,全球仅批准了数量有限的涉及干细胞的治疗; |
| ● | 干细胞领域存在大量的知识产权纠纷。 |
GIO开发的基于干细胞的疗法的监管要求可能会发生变化。在更广泛的干细胞领域,GIO知道获得FDA和EMA上市许可的干细胞疗法数量有限。即使相对于更成熟的Treatments,监管环境仍在发展。管理干细胞治疗的监管要求经常发生变化,将来可能会继续变化。此外,在负责管理现有治疗的人员方面存在大量的、有时是不协调的重迭。由他人进行的干细胞疗法临床试验中的严重不良事件或进展,可能会导致FDA或其他监管机构对GIO的临床试验发起临床暂停,或以其他方式改变批准GIO的任何疗法的要求。虽然FDA决定是否可以进行个别方案,但其他审查机构的审查过程和决定可能会阻碍或延迟临床试验的启动,即使FDA已经审查了试验并批准了试验的启动。
欧洲联盟也是如此。EMA的先进疗法委员会(CAT)负责评估先进疗法治疗的质量、安全性和有效性。禁止酷刑委员会的职责是就一种疗法或其他新型治疗性药物候选者的上市许可申请编写一份意见草案,在CHMP通过其最终意见之前提交给人用药品委员会(“CHMP”)。在欧洲联盟,必须在欧洲联盟有关准则的范围内考虑开发和评价一种先进的治疗性医药产品。EMA可能会发布有关这些药物治疗的开发和上市许可的新指南,并要求GIO遵守这些新指南。因此,适用于干细胞治疗的程序和标准可能适用于GIO的治疗,但目前仍不确定。
干细胞治疗的上市后经验或其他人进行的临床试验中的不利发展可能导致FDA、EMA和其他监管机构修订GIO治疗的开发或批准要求,或者可能
96
开发或限制使用干细胞技术的Treatments,这两种技术都可能对GIO的业务造成重大损害。此外,FDA、EMA和其他监管机构的临床试验要求,以及这些监管机构用来确定一种治疗的安全性和有效性的标准,根据潜在治疗的类型、复杂性、新颖性和预期用途以及市场而有很大差异。新疗法的监管审批过程可能比其他更知名或更广泛研究的药物或其他疗法更昂贵和耗时更长。管理现有或未来规章或立法的管理机构不得允许及时或在技术上或商业上可行的条件下生产和销售利用干细胞进行的治疗。此外,监管行动或私人诉讼可能会导致GIO的Treatment开发、研究项目或由此产生的Treatments的商业化产生费用、延误或其他障碍。
上述监管审查和咨询小组及其颁布的新准则可能会延长监管审查过程,要求GIO进行更多的研究或试验,增加其开发成本,导致监管立场和解释发生变化,延迟或阻止这些候选治疗药物的批准和商业化,或导致批准后的重大限制或限制。随着GIO推进其治疗和研究项目,GIO将被要求与这些监管和咨询小组协商,并遵守适用的准则。如果GIO未能做到这一点,它可能会被要求推迟或停止GIO的Treatments的开发。
GIO可能会不时公布或公布的临床试验的中期“顶线”和初步结果,可能会随着更多患者数据的出现而发生变化,并受到可能导致最终数据发生重大变化的审计和核实程序的约束。
GIO可能会不时公布任何未来临床前研究和临床试验的临时顶线或初步结果,这些结果是基于对当时可获得的数据的初步分析,在对与特定研究或试验相关的数据进行更全面的审查后,结果和相关发现和结论可能会发生变化。GIO可能完成的临床试验的中期结果存在这样的风险:随着患者登记的继续和更多患者数据的提供,一项或多项临床结果可能会发生重大变化。初步或顶线结果也仍需经过审计和核查程序,这可能导致最终数据与GIO先前公布的初步数据存在重大差异。因此,在获得最终数据之前,应谨慎看待临时和初步数据。初步或中期数据与最终数据之间的差异可能会严重损害GIO的业务前景,并可能导致GIO普通股的交易价格大幅波动。
此外,包括监管机构在内的其他机构可能不接受或不同意GIO的假设、估计、计算、结论或分析,或者可能以不同方式解释或权衡数据的重要性,这可能会影响特定项目的价值、特定治疗或产品的批准或商业化,以及一般的GIO。此外,GIO选择公开披露的有关某项研究或临床试验的信息是基于通常广泛的信息,投资者或其他人可能不同意GIO确定的重要信息或其他适当信息应包含在其披露中,而GIO决定不披露的任何信息最终可能被视为对未来的决定、结论、观点、活动或与特定治疗或GIO业务有关的其他方面具有重要意义。如果GIO报告的中期、顶线或初步数据与实际结果不同,或者包括监管机构在内的其他机构不同意所得出的结论,GIO获得批准并将其Treatments商业化的能力可能会受到损害,这可能会损害GIO的业务、经营业绩、前景或财务状况。
对干细胞疗法的负面舆论,以及对干细胞研究监管审查的加强,可能会对公众对GIO未来疗法的看法产生负面影响。
GIO的治疗涉及干细胞的使用。GIO的潜在疗法能否在临床和商业上取得成功,在一定程度上将取决于公众对干细胞使用的接受程度。公众的态度可能会受到干细胞疗法不安全、不道德或不道德的说法的影响,因此,GIO的疗法可能无法获得公众或医学界的认可。公众的负面态度可能会对GIO注册临床试验的能力产生不利影响。此外,GIO的成功将取决于患者是否愿意接受治疗。GIO可能会替代或补充他们已经熟悉的现有疗法,并可能获得更多的临床数据。
更严格的政府监管或负面舆论将对GIO的业务或财务状况产生负面影响,并可能延迟或损害其Treatments的开发和商业化,或一旦获得批准,对任何Treatments的需求。GIO临床试验中的不良事件,即使不是最终归因于其Treatments,以及由此引起的宣传,可能会导致政府监管增加、公众看法不佳、GIO Treatments的测试或批准可能出现监管延迟、对已获批准的Treatments的更严格标签要求,以及对任何此类治疗的需求下降
97
治疗。如果发生任何此类不良事件,GIO治疗的商业化或临床试验的进一步推进可能会被暂停或推迟,这将对其业务和运营产生负面影响。
GIO可能会为其部分或全部治疗寻求快速通道指定。GIO可能不会获得这样的指定,即使对于它这样做的治疗,它可能不会导致更快的开发或监管审查或批准过程,也不会增加治疗获得上市批准的可能性。
GIO可能会寻求快速通道指定和审查其部分或所有其他治疗。如果一种药物或生物制剂用于治疗严重或危及生命的疾病或疾病,而非临床或临床数据表明有可能解决未满足的医疗需求,则该产品可能有资格获得FDA快速通道认定,申办者必须申请该认定。如果获得批准,快速通道的认定将使一个产品有资格与FDA进行更频繁的互动,讨论开发计划和临床试验设计,以及对申请进行滚动审查,这意味着该公司可以在完成整个提交之前提交其营销申请的完整部分,以供审查。根据FDA提供的政策和程序,具有快速通道指定的治疗的营销申请可能有资格获得优先审查,但快速通道指定并不能保证FDA的任何此类资格或最终营销批准。FDA拥有广泛的自由裁量权,可以决定是否授予这一称号。因此,即使GIO认为某个特定的治疗有资格获得这一称号,FDA也可能决定不授予它。此外,即使GIO确实获得了快速通道指定,与传统的FDA程序相比,GIO或其合作者可能不会经历更快的开发过程、审查或批准。此外,如果FDA认为GIO临床开发项目的数据不再支持快速通道的认定,它可能会撤销快速通道的认定。
GIO可能会为其治疗方案寻求优先审评指定,但GIO可能不会获得这种指定,即使获得了,这种指定也可能不会导致更快的开发或监管审查或批准过程。
如果FDA确定一种治疗提供一种针对严重疾病的治疗,并且如果获得批准,该产品将在安全性或有效性方面提供重大改进,FDA可以指定该治疗进行优先审查。优先审评认定意味着FDA审查申请的目标是六个月,而不是十个月的标准审查期。对于是否给予治疗优先审评地位,FDA拥有广泛的自由裁量权,因此,即使GIO认为特定的治疗有资格获得这种指定或地位,FDA也可以决定不给予它。此外,优先审评的指定并不一定意味着更快的开发或监管审评或批准过程,也不一定意味着与传统的FDA程序相比在批准方面有任何优势。接受FDA的优先审评并不能保证在六个月的审评周期内获得批准,或者根本不能保证获得批准。
即使GIO的任何疗法获得FDA的突破性疗法认定,也不会带来更快的开发或监管审查或批准过程,也不会增加GIO的疗法获得上市批准的可能性。
如果临床数据支持一种或多种治疗的突破性治疗指定,GIO可以为其治疗寻求突破性治疗指定。突破性疗法被定义为一种药物或生物制剂,其目的是单独或与一种或多种其他药物或生物制剂联合使用,以治疗严重或危及生命的疾病或状况,而初步临床证据表明,该药物或生物制剂可能在一个或多个临床重要终点(如在临床开发早期观察到的实质性治疗效果)上显示出比现有疗法有显著改善。对于被指定为突破性疗法的治疗,FDA和试验发起者之间的互动和沟通可以帮助确定临床开发的最有效路径,同时最大限度地减少被置于无效控制方案中的患者数量。被FDA指定为突破性疗法的药物和生物制剂也可能有资格获得加速批准。
被指定为突破性疗法是在FDA的自由裁量权范围内。因此,即使GIO认为其中一种疗法符合被指定为突破性疗法的标准,FDA也可能不同意并决定不进行此类指定。在任何情况下,获得治疗突破性治疗指定可能不会导致更快的开发过程、审查或批准,与根据非快速FDA审查程序考虑批准的药物相比,也不能保证FDA最终批准。此外,即使GIO的一项或多项Treatments符合突破性疗法的条件,FDA也可能会在以后判定该产品不再符合资格条件。
98
FDA和其他政府机构因资金短缺或全球健康问题而出现的混乱,可能会妨碍它们聘用、保留或部署关键领导和其他人员的能力,或以其他方式阻止新的或改良的Treatments及时开发、批准或商业化,或根本无法实现,这可能会对GIO的业务产生负面影响。
FDA审查和批准新疗法的能力可能受到多种因素的影响,包括政府预算和资金水平、法规、监管和政策变化、FDA雇佣和留住关键人员以及接受用户付费的能力,以及其他可能影响FDA履行日常职能能力的事件。因此,近年来该机构的平均审查时间有所波动。此外,政府为资助研究和发展活动的其他政府机构提供的资金受制于政治进程,而政治进程本身就是不稳定和不可预测的。FDA和其他机构的中断也可能会延缓新的生物制剂或对已批准或已获批准的生物制剂的修改需要经过必要的政府机构审查和/或批准的时间,这将对GIO的业务产生不利影响。例如,为应对新冠疫情,2020年3月10日,FDA宣布打算推迟对国外生产设施的大部分检查,2020年3月18日,FDA暂时推迟了对国内生产设施的例行监督检查。随后,在2020年7月10日,FDA宣布打算恢复对国内生产设施的某些现场检查,但须遵守基于风险的优先排序制度。美国以外的监管当局可针对新冠疫情采取类似的限制措施或其他政策措施。如果政府长期停摆,或者如果全球健康问题继续阻碍FDA或其他监管机构进行定期检查、审查或其他监管活动,可能会严重影响FDA或其他监管机构及时审查和处理GIO提交的监管文件的能力,这可能会对GIO的业务产生重大不利影响。
与GIO与第三方关系相关的风险
GIO将依赖第三方来进行临床前和临床试验,并将依赖第三方为其执行其他任务。如果这些第三方不能成功地履行其合同义务,不能满足预期的最后期限或遵守监管要求,GIO可能无法获得监管机构对其治疗的批准或将其商业化,其业务可能受到严重损害。
GIO的管理团队在开展临床试验方面经验有限。此外,GIO不具备独立开展临床前研究和临床试验的能力,GIO预计将依赖医疗机构、临床研究人员、合同实验室和其他第三方或CRO为其治疗方案开展临床前研究和未来临床试验。GIO预计将在很大程度上依赖这些各方执行其治疗的临床前和未来临床试验,并仅控制其活动的某些方面。尽管如此,GIO将负责确保其每项临床前和临床试验都按照适用的协议、法律和监管要求以及科学标准进行,GIO对CRO的依赖不会解除其监管责任。对于GIO在开展临床前研究和临床试验过程中的任何违法违规行为,GIO可能会受到警告函或执法行动的处罚,其中可能包括民事处罚,甚至包括刑事起诉。
将要求GIO及其CRO遵守规定,包括开展、监测、记录和报告临床前和临床试验结果的cGCP,以确保数据和结果在科学上可信和准确,并确保试验患者充分了解参与临床试验的潜在风险,并保护他们的权利。这些条例由FDA、欧洲经济区成员国主管当局和类似的外国监管当局对临床开发中的任何产品执行。FDA通过定期检查临床试验赞助者、主要研究者和试验地点来执行cGCP法规。如果GIO或其CRO未能遵守适用的cGCP,其临床试验中产生的临床数据可能被视为不可靠,FDA或类似的外国监管当局可能要求GIO在批准其上市申请之前进行额外的临床试验。GIO不能向你保证,在检查后,FDA将确定GIO未来的任何临床试验都将符合cGCP。此外,GIO的临床试验必须使用按照FDA当前cGMP要求生产的Treatments。GIO未能或其CRO未能遵守这些规定,可能要求GIO重复临床试验,这将延迟监管审批程序,还可能使GIO受到执法行动的影响。
尽管GIO打算为其Treatments设计计划中的临床试验,但在可预见的未来,CRO将进行GIO计划中的所有临床试验。因此,GIO开发项目的许多重要方面,包括其行为和时间安排,将不受其直接控制。GIO依赖第三方来进行未来的临床前研究和临床试验,这也将导致GIO对通过临床前研究和临床试验开发的数据的管理的日常控制低于完全依赖自己员工的情况。
99
如果GIO与这些第三方CRO的任何关系终止,GIO可能无法与其他CRO达成协议。如果CRO不能成功地履行其合同义务或履行预期的最后期限,如果它们需要被替换,或者由于未能遵守GIO的临床方案、监管要求或其他原因,它们所获得的临床数据的质量或准确性受到损害,与这些CRO相关的任何临床前研究或临床试验可能会被延长、延迟或终止。在这种情况下,GIO可能无法获得其治疗的监管批准或成功地将其商业化。其结果是,GIO的财务业绩和其治疗对象适应症的商业前景可能受到损害,GIO的成本可能增加,其创收能力可能被推迟。
GIO的Treatments的临床供应将依赖第三方制造商。如果这些制造商损失,或这些制造商未能遵守FDA的规定,GIO可能无法以商业上合理的条件找到替代来源,或根本无法找到。此外,第三方制造商和任何第三方合作者可能无法以足够的质量和数量成功扩大GIO的Treatments的生产,这将延迟或阻止GIO开发其Treatments并将批准的Treatments商业化(如果有的话)。
GIO目前没有任何制造设施。GIO将依赖第三方制造商来制造和供应其用于临床前研究的材料,并预计它将继续这样做,以用于未来的临床测试和GIO可能开发的、GIO或其合作者获得营销批准的治疗的商业供应。GIO与GIOSTAR的协议包括对其在未经GIOSTAR同意的情况下与任何其他供应商达成供应协议的能力进行某些限制。GIO可能无法与第三方制造商或供应商维持或建立任何协议,或无法以可接受的条款这样做。即使GIO能够与第三方制造商或供应商订立协议,对第三方制造商的依赖也会带来额外的风险,包括:
| ● | 第三方可能违反制造或供应协议; |
| ● | 第三方可能在对GIO来说代价高昂或不方便的时候终止或不续签协议;以及 |
| ● | 在监管合规、质量保证、安全和药物警戒及相关报告方面依赖第三方。 |
第三方制造商可能无法遵守美国以外的cGMP法规或类似的监管要求。GIO未能或其第三方制造商或供应商未能遵守适用法规,可能导致对GIO的制裁,包括罚款、禁令、民事处罚、延迟、暂停或撤销批准、吊销许可证、扣押或召回Treatments、运营限制和刑事起诉,其中任何一项都可能对GIO的Treatments供应产生重大不利影响,并损害GIO的业务、财务状况、运营结果和前景。
GIO的Treatments可能会与其他公司竞争制造设施和其他供应。根据cGMP规定运营的制造商数量有限,可能有能力为GIO生产。此外,在批准其Treatments之前,GIO需要确定一家合同制造商,该制造商能够以商业规模生产其Treatments,并能够成功完成FDA批准前的检查和其他卫生当局的检查。在GIO需要具备这种能力和能力时,它可能无法获得与这些制造商或供应商的协议。
GIO现有或未来制造商或供应商的任何性能故障,或制造商或供应商决定将其Treatments撤出市场或限制其Treatments的准入,都可能延迟临床开发或上市批准。GIO目前没有为其目前在临床试验或临床前研究中使用的许多材料作出冗余或保证供应的安排,GIO可能难以或无法确定这些材料的替代来源。
GIO可能与第三方合作,研究、开发和商业化其可能开发的某些疗法。如果任何此类合作不成功,GIO可能无法利用这些治疗的市场潜力。
GIO可能会为其可能开发的某些疗法的研究、开发和商业化寻求第三方合作者。如果GIO与任何第三方达成任何此类安排,它对合作者投入GIO的Treatments开发或商业化的资源数量和时间的控制可能有限。GIO的生成能力
100
这些安排的收入将取决于合作者能否成功履行这些安排中分配给他们的职能。GIO无法预测它参与的任何合作的成功。
涉及GIO的治疗或研究项目的合作给GIO带来了许多风险,包括:
| ● | 合作者可能不会追求GIO治疗的开发和商业化,也可能会选择不继续或更新基于临床试验结果、合作者战略重点或可用资金变化或外部因素的开发或商业化项目,例如转移资源或创造相互竞争的优先事项的收购。 |
| ● | 合作者可能会延迟临床试验,为临床试验项目提供不足的资金,停止临床试验或放弃治疗,重复或进行新的临床试验,或要求新的治疗方案用于临床试验。 |
| ● | 合作者可以独立开发或与第三方合作开发与GIO的Treatments直接或间接竞争的Treatments,前提是合作者认为竞争性的Treatments更有可能被成功开发,或者可以按照比GIO更具经济吸引力的条款进行商业化。 |
| ● | 拥有一种或多种疗法的营销和分销权利的合作者可能不会为此类疗法的营销和分销投入足够的资源。 |
| ● | 合作者可能无法正确获取、保护、维护、执行或捍卫GIO的知识产权或专有权利,或者可能会使用GIO的专有信息,从而引发可能危及GIO的专有信息或使其无效的诉讼,或使GIO面临潜在诉讼。 |
| ● | 合作者与GIO之间可能发生纠纷,导致GIO治疗的研究、开发或商业化的延迟或终止,或导致代价高昂的诉讼或仲裁,转移管理层的注意力和资源。 |
| ● | 在GIO合作中发现的情况下,GIO可能会失去某些有价值的权利,包括在GIO发生控制权变更的情况下。 |
| ● | 合作协议可能不会以最有效的方式或根本不会导致治疗的开发或商业化。如果GIO未来的合作者参与业务合并,那么在这种合作下对GIO产品开发或商业化计划的追求和重视可能会被推迟、削弱或终止。 |
如果GIO的合作未能导致Treatments的成功开发和商业化,或者如果GIO的合作者之一终止了与GIO的协议,GIO可能不会根据合作获得任何未来的研究资金、里程碑或特许权使用费。如果GIO得不到这些协议所要求的资金,GIO开发Treatments的工作可能会被推迟,GIO可能需要额外的资源来开发Treatments。此外,如果GIO的合作者之一终止与它的协议,GIO可能会发现更难找到合适的替代合作者或吸引新的合作者,GIO的开发计划可能会被推迟,或者商业和金融界对GIO的看法可能会受到不利影响。本代理声明/招股说明书中描述的与产品开发、监管批准和商业化有关的所有风险都适用于GIO合作者的活动。
这些关系,或类似的关系,可能要求GIO产生非经常性和其他费用,增加其近期和长期支出,发行稀释其现有股东的证券,或扰乱其管理和业务。
如果GIO无法以商业上合理的条款建立合作,GIO可能不得不改变其开发和商业化计划。
GIO的产品开发和研究项目,以及GIO可能开发的任何疗法的潜在商业化,都需要大量额外的现金来支付费用。对于GIO可能开发的某些疗法,它可能会决定与制药和生物技术公司合作开发这些疗法并将其商业化。
在寻找合适的合作者方面,GIO可能面临巨大的竞争。GIO是否就合作达成最终协议,除其他外,将取决于GIO对合作者资源和专业知识的评估、拟议合作的条款和条件,以及拟议合作者对许多因素的评估。这些因素可能包括
101
临床试验的设计或结果、FDA、EMA或美国以外类似监管机构批准的可能性、治疗主题的潜在市场、制造和向患者提供治疗的成本和复杂性、竞争性治疗的可能性、GIO的技术所有权是否存在不确定性(如果不考虑挑战的优劣而对这种所有权提出质疑),以及行业和市场的总体状况。合作者还可考虑可供合作的类似适应症的替代疗法或技术,以及这种合作是否比与GIO的合作更具吸引力。
根据现有的合作协议,GIO也可能受到限制,不能与潜在的合作者按某些条款订立未来的协议。协作是复杂和耗时的谈判和文件。此外,大型制药公司最近进行了大量业务合并,导致未来潜在合作者的数量减少。
GIO可能无法及时、以可接受的条件或根本无法谈判合作。如果GIO无法做到这一点,它可能不得不限制GIO寻求合作的治疗的开发,减少或推迟其开发项目或GIO的一个或多个其他开发项目,推迟其潜在的商业化或缩小任何销售或营销活动的范围,或增加GIO的支出,并自费进行开发或商业化活动。如果GIO选择增加支出,自行为开发或商业化活动提供资金,GIO可能需要获得额外的资本,但可能无法以可接受的条件或根本无法获得这些资本。如果GIO没有足够的资金,它可能无法开发Treatments或将其推向市场并产生产品收入。
GIO将依靠GIOSTAR提供AHSDM。
GIO将依靠GIOSTAR提供AHSDM。根据GIOSTAR供应协议,GIOSTAR同意在交割后的四年内向GIO提供一定数量的AHSDM。GIOSTAR在为GIO制造AHSDM的过程中可能会遇到延迟或其他制造问题。如果GIOSTAR无法生产并向GIO交付AHSDM,或者GIOSTAR提供的AHSDM的质量或纯度有问题,那么GIO的Active Cosmetics业务线可能会受到不利影响。
GIO可能依赖第三方医疗服务提供商,后者为GIO的抗衰老诊所提供许可。
如果GIO选择与第三方医疗供应商达成许可协议,为其抗衰老诊所提供许可,那么GIO将依赖这些第三方医疗供应商按照许可协议开展业务,并按照GIO的协议提供服务。如果第三方医疗服务提供商对患者产生不良影响,或患者因抗衰老诊所的服务而受伤,GIO的声誉可能受到损害,这可能对GIO的业务和经营业绩产生不利影响。
GIO可能会依赖现有的化妆品公司来购买AHSDM。
在其Active Cosmetics系列产品中,GIO可能寻求开发和制造自己的Treatments,或者GIO可能与现有化妆品公司签订协议,销售用于这些化妆品公司Treatments的AHSDM。如果GIO无法与现有化妆品公司建立关系,或者如果GIO无法以经济上可行的条款与现有化妆品公司达成协议,GIO的业务可能会受到不利影响,GIO的Active Cosmetics系列可能会受到影响。
与GIO知识产权相关的风险
GIO高度依赖从第三方获得许可的知识产权,终止任何此类许可,或对此类许可所涵盖的知识产权提出质疑,都可能导致重大权利的丧失,从而损害其业务。
GIO依赖从第三方获得许可的专门知识和专有技术来开发其疗法,如果获得批准,则将其商业化。这些许可的任何终止,或发现此类知识产权缺乏法律效力,都可能导致重大权利的丧失,并可能损害GIO将其Treatments商业化的能力。
GIO与第三方签订的每一份许可协议都将对GIO规定某些义务,包括努力达到开发门槛和付款义务的义务。不遵守这些义务可能导致终止
102
各自的许可协议或在法律和财务方面的后果。如果GIO的任何许可方终止其各自的许可协议,GIO可能无法开发或商业化这些协议涵盖的Treatments。终止GIO的许可协议,或减少或取消GIO在这些协议下的权利,可能导致GIO不得不谈判一项新的或恢复的协议,而GIO可能无法以同样优惠的条款获得该协议,或根本无法获得该协议,这可能意味着GIO无法开发、商业化或销售受影响的治疗,或可能导致GIO失去其在许可协议下的权利,或不得不根据许可协议支付更高的金额。
此外,GIO的许可方可能会在起诉、维护、执行和捍卫任何可能不符合GIO最佳利益的许可知识产权方面做出决定。如果GIO的许可方就任何许可知识产权采取任何行动,导致第三方成功挑战许可知识产权,则此类知识产权可能会被作废或被认定为不可执行,GIO可能会失去其在此类知识产权下的权利,这可能会对GIO的业务造成重大损害。GIO的许可方也可能未能对商业秘密或其他机密许可知识产权保密,或未能对第三方实施许可知识产权,这可能有利于GIO的竞争对手,并对GIO的业务造成重大损害。此外,商业秘密所有权问题是一个复杂的问题,它高度依赖于各种因素,如涉及商业秘密的各方之间是否有转让协议、这些各方之间的关系以及这些各方之间的接触范围。如果错误的一方声称对商业秘密拥有所有权,那么任何盗用或窃取商业秘密的行动都可能无法执行,而GIO作为被许可人将没有追索权。
此外,GIO目前许可知识产权所依据的协议以及它们今后可能与第三方订立的协议是复杂的,此类协议中的某些条款可能会有多种解释。因此,GIO与其许可方之间可能在受许可协议约束的知识产权方面产生争议。解决可能出现的任何合同解释分歧,可能会缩小GIO认为的GIO对相关知识产权或技术的权利范围,或增加GIO认为其在相关协议下的财务或其他义务。如果GIO已获得许可的知识产权纠纷妨碍或损害其以可接受的条款维持其现有许可安排的能力,或不足以向GIO提供使用知识产权的必要权利,则GIO可能无法成功开发受影响的治疗并将其商业化。
GIO在商业上的成功取决于其获取、维护和保护其知识产权和专有技术的能力。
GIO的商业成功在很大程度上取决于其通过商业秘密获取、维护和保护知识产权的能力,或者知道如何在美国和其他国家使用GIO专有的Treatments。如果GIO不充分保护其知识产权,竞争对手可能会侵蚀、否定或抢占GIO可能拥有的任何竞争优势,这可能会损害GIO的业务和实现盈利的能力。
如果GIO不能保护其商业秘密的机密性,其商业和竞争地位可能受到损害。
GIO将依靠商业秘密保护、专门知识和持续的技术创新来发展和保持其竞争地位。GIO将通过与承包商、合作者、科学顾问、雇员和顾问签订保密协议以及与顾问和雇员签订发明转让协议,寻求保护其专有技术和工艺。然而,GIO可能不会在所有情况下获得这些协议,与GIO有这些协议的个人可能不会遵守这些协议的条款。这些协议下的知识产权转让可能不是自动执行的,或者转让协议可能被违反,GIO可能被迫向第三方提出索赔,或为他们可能向GIO提出的索赔进行辩护,以确定GIO视为GIO知识产权的所有权。此外,尽管存在保密协议和其他合同限制,但GIO可能无法防止这些协议的当事方未经授权披露或使用GIO的技术诀窍或其他商业秘密。监测未经授权的使用和披露是困难的,GIO不知道GIO为保护其专有技术而采取的措施是否有效。如果作为这些协议当事方的承包商、合作者、科学顾问、雇员和顾问中的任何一方违反或违反这些协议的任何条款,GIO可能没有对任何此类违反或违反的适当补救办法。因此,GIO可能会失去其商业机密。向非法获取并使用GIO商业机密的第三方(如专利诉讼)提出索赔,既昂贵又耗时,而且结果不可预测。此外,美国以外的法院有时不太愿意或不愿意保护商业秘密。上述任何一项都可能对GIO的业务、财务状况、经营业绩和前景产生重大不利影响。
此外,GIO的商业秘密可能会被GIO的竞争对手或其他第三方知晓或独立发现。竞争对手和其他第三方可以尝试复制GIO获得的部分或全部竞争优势
103
从其开发努力中,故意侵犯GIO的知识产权,围绕GIO的受保护技术进行设计,或者开发属于GIO知识产权范围之外的有竞争力的技术。如果GIO的任何商业秘密是由竞争对手或其他第三方合法获取或独立开发的,GIO将无权阻止他们或他们与之交流的人使用该技术或信息与GIO竞争。如果GIO的商业秘密得不到充分保护,或者不足以提供相对于GIO竞争对手的优势,GIO的竞争地位可能会受到不利影响,GIO的业务也会受到不利影响。此外,如果为维护GIO的商业秘密而采取的措施被认为是不充分的,那么GIO可能没有足够的追索权,因为第三方盗用了GIO的商业秘密。
如果GIO的商标和商品名称得不到充分保护,那么GIO可能无法在其感兴趣的市场上建立知名度,其业务可能会受到不利影响。
GIO当前或未来的商标或商品名称可能会受到质疑、侵犯、规避或被宣布为通用或描述性商标,或被确定为侵犯其他商标。GIO可能无法保护其对这些商标和商品名称的权利,或者可能被迫停止使用这些名称,GIO需要这些名称才能在其感兴趣的市场上得到潜在合作伙伴或客户的认可。GIO的公司名称和标识,以及Treatment的名称,都不是注册商标。如果GIO寻求注册其任何商标,在商标注册程序中,GIO可能会收到美国专利商标局或其他外国司法管辖区对其申请的拒绝。虽然GIO将有机会对这些拒绝作出回应,但它可能无法克服这些拒绝。此外,在美国专利商标局和许多外国法域的类似机构中,第三方有机会反对未决的商标申请,并寻求撤销注册商标。可能会对GIO的商标提起异议或撤销诉讼,而GIO的商标可能无法通过此类诉讼。如果GIO无法根据其商标和商品名称建立名称识别,则可能无法有效竞争,其业务可能受到不利影响。GIO可将其商标和商号授权给第三方,如分销商。虽然这些许可协议可能为如何使用GIO的商标和商号提供指导,但违反这些协议或被许可人滥用其商标和商号可能会危及GIO的权利或削弱与其商标和商号相关的商誉。
此外,GIO提议在美国使用的任何名称都必须得到FDA的批准,无论GIO是否已将其注册为商标,或申请将其注册为商标。欧洲也有类似的要求。FDA通常会对拟议的产品名称进行审查,包括评估与其他产品名称混淆的可能性。如果FDA(或外国司法管辖区的同等行政机构)反对GIO提议的任何专利产品名称,GIO可能需要花费大量额外资源,以确定一个符合适用商标法的条件、不侵犯第三方现有权利并为FDA所接受的合适替代名称。此外,在许多国家,拥有和维持商标注册可能无法对高级商标所有人随后提出的侵权主张提供充分的抗辩。有时,竞争对手或其他第三方可能采用与GIO类似的商号或商标,从而阻碍GIO打造品牌形象的能力,并可能导致市场混乱。此外,其他注册商标或包含其注册或未注册商标或商号变体的商标的所有人可能会提出商标名称或商标侵权索赔。如果GIO主张商标侵权,法院可以裁定GIO主张的商标无效或不可执行,或者GIO主张商标侵权的当事人对有关商标享有优先权利。在这种情况下,GIO最终可能被迫停止使用此类商标。
我们可能无法成功地获得或许可其治疗基础的关键技术的必要权利。
GIO目前通过第三方许可拥有知识产权,以开发其Treatments,GIO未来可能寻求扩大其与Treatment管道相关的知识产权足迹,部分方式是对关键技术的权利进行许可。GIO业务的未来增长将部分取决于其获得许可或以其他方式获得开发更多治疗和技术的权利的能力。GIO不能保证它能够以可接受的条件或根本不能保证从第三方获得与其治疗有关的其他技术的许可或权利。
为了推销GIO的Treatments,GIO可能会发现有必要或谨慎地从第三方知识产权持有者那里获得许可。然而,可能不清楚谁拥有GIO希望获得的知识产权,或者GIO可能无法获得此类许可,或者无法以其他方式从第三方获得或在许可范围内获得其认为对其可能开发的治疗和使用的技术所必需的知识产权。
第三方知识产权的许可或获取是一个竞争激烈的领域,其他公司可能会采取战略,许可或获取GIO可能认为有吸引力或必要的第三方知识产权。这些公司可能比GIO具有竞争优势,例如,由于其规模、资本资源和更大的临床开发和
104
商业化能力。此外,认为GIO是竞争对手的公司可能不愿向其转让或授权权利。GIO也可能无法按照允许其投资获得适当回报的条件或根本无法获得许可或获取第三方知识产权。如果GIO无法成功获得所需的第三方知识产权的权利或维持GIO拥有的现有知识产权,GIO可能不得不放弃相关项目或治疗的开发,这可能对GIO的业务、财务状况、运营结果和前景产生重大不利影响。
即使GIO能够获得这样的许可,它也可能是非排他性的,从而让GIO的竞争对手和其他第三方获得许可给GIO的相同技术,并可能要求GIO支付大量的许可和专利使用费。如果GIO无法以商业上合理的条款获得第三方专利的必要许可,GIO可能无法将其Treatments商业化,或者此类商业化努力可能被大幅推迟,这进而可能严重损害GIO的业务。
第三方对知识产权侵权、盗用或其他侵权行为的指控可能会阻止或延迟GIO的产品发现和开发工作,并对其业务产生重大不利影响。
GIO的商业成功在一定程度上有赖于GIO避免侵犯、盗用和其他侵犯第三方专利和所有权的行为。在生物技术和制药行业存在大量涉及专利和其他知识产权的诉讼,以及对专利提出质疑的行政诉讼,包括在美国专利商标局或外国法域的反对和其他类似诉讼之前的干涉和复审程序。最近,在美国专利改革下,包括当事人间审查和授权后审查在内的新程序开始实施。这一改革将给GIO未来可能获得的任何专利提出质疑的可能性带来不确定性。在GIO开发Treatments的领域中,存在着大量由第三方拥有的美国和外国颁发的专利和待批专利申请,第三方可能会声称他们拥有包括GIO的Treatments、技术或方法在内的专利权。第三方可能会声称GIO在未经授权的情况下使用其专有技术,并可能对GIO提出专利侵权索赔或诉讼,如果GIO被发现侵犯了此类第三方专利,GIO可能会被要求支付损害赔偿金、停止侵权技术的商业化或从此类第三方获得许可,这些许可可能无法以商业上合理的条款获得,或者根本无法获得。
对于与使用或制造GIO的Treatments相关的材料、配方、制造方法或治疗方法,可能存在具有专利权的第三方专利。由于专利申请可能需要多年时间才能发布,目前可能会有一些待批专利申请,这些申请可能会导致GIO的Treatments可能侵犯的已发布专利。此外,第三方可能会在未来获得专利,并声称使用GIO的技术侵犯了这些专利。此外,GIO或其许可方甚至可能无法识别已经发布或可能错误解释此类专利的相关性、范围或到期的相关第三方专利。专利权利要求的范围取决于对法律的解释、专利的书面披露以及专利的起诉历史。GIO对一项专利或一项待决申请的相关性或范围的解释可能是不正确的。如果有管辖权的法院持有任何第三方专利,以涵盖GIO的Treatments的制造过程、制造过程中使用或形成的材料或任何最终产品本身或其使用过程,则任何此类专利的持有者可能能够阻止GIO将该Treatment商业化的能力,除非GIO根据适用的专利获得许可,或者在此类专利到期或最终被确定为无效或不可执行之前。同样,如果有管辖权的法院持有任何第三方专利,以涵盖GIO的材料、配方或方法的各个方面,包括但不限于联合疗法或患者选择方法,则任何此类专利的持有人可能会阻止GIO开发治疗并将其商业化的能力,除非GIO获得许可,或者在此类专利到期或最终被确定为无效或不可执行之前。
对GIO提出索赔的各方可以寻求并获得禁令或其他公平救济,这可能会有效阻止GIO进一步开发和商业化其Treatments的能力。为这些索赔辩护,无论其价值如何,都将涉及巨额诉讼费用,并将大量转移GIO业务的员工资源。GIO可能没有足够的资源来让这些行动圆满结束,这可能会导致巨大的成本,并可能阻碍GIO无法进行任何受影响的治疗。还可以公开宣布听讯、动议或其他临时程序或事态发展的结果。如果证券分析师或投资者认为这些结果是负面的,可能会对GIO普通股的股价产生重大不利影响。
如果针对GIO的侵权索赔成功,GIO可能需要支付巨额赔偿金,包括三倍赔偿金和故意侵权的律师费,从第三方获得一个或多个许可,支付版税或重新设计GIO的侵权治疗,这可能是不可能的,或者需要大量的时间和金钱支出。
105
GIO已获得许可或未来可能获得许可的一些知识产权可能是通过政府资助的项目发现的,因此可能受到联邦法规的约束,例如“进入”权利、某些报告要求以及对美国公司的偏好。遵守这些规定可能会限制GIO的独家权利,并限制GIO与非美国制造商签订合同的能力。
GIO已授权或未来可能授权的任何知识产权,以及通过使用美国政府资金产生的知识产权,均受某些联邦法规的约束。因此,根据1980年的《拜多勒法》(Bayh-Dole Act),美国政府可能对GIO当前或未来的待遇中包含的知识产权拥有某些权利。在政府资助的项目下开发的某些发明的这些美国政府权利包括一项非排他性、不可转让、不可撤销的全球许可,可将发明用于任何政府目的。此外,美国政府有权要求GIO向第三方授予任何此类知识产权的排他性、部分排他性或非排他性许可,前提是该政府认定:
| ● | 尚未采取适当步骤将该发明商业化; |
| ● | 政府行动是满足公众健康或安全需要所必需的;或 |
| ● | 政府必须采取行动,以满足联邦法规(也被称为“进入权利”)规定的公众使用要求。 |
如果GIO或适用的许可方没有向政府披露发明,也没有在规定的时限内提交注册知识产权的申请,美国政府也有权取得这些知识产权的所有权。在政府资助的方案下产生的知识产权也须遵守某些报告要求,遵守这些要求可能需要GIO或适用的许可方花费大量资源。GIO不能确定其当前或未来的许可方是否将始终遵守《Bayh-Dole法》的披露或报告要求,或是否能够在遵守这些要求的情况下纠正任何失误。
此外,美国政府要求,任何体现主题发明或通过使用主题发明而生产的治疗,基本上都是在美国制造的。如果知识产权所有人能够证明作出了合理但不成功的努力,以类似的条件向可能大量在美国制造的潜在被许可人发放许可证,或者在这种情况下国内制造在商业上不可行,则可以放弃制造优惠要求。这种对美国制造商的偏好,可能会限制GIO与非美国产品制造商签订此类知识产权涵盖的Treatments合同的能力。如果GIO当前或未来的任何知识产权是通过使用美国政府资金产生的,《拜多法》的条款可能同样适用。
GIO可能卷入保护或强制执行其知识产权的诉讼,这可能是昂贵、耗时和不成功的。
竞争对手可能侵犯或盗用GIO的商标、商业秘密、诀窍或其他知识产权。为了应对侵权或未经授权的披露或使用,GIO可能会被要求提出侵权或盗用索赔,这可能既昂贵又耗时,还会分散GIO管理层和科研人员的时间和注意力。GIO针对被认为是侵权者或盗用行为提出的任何主张,都可能促使这些当事方对GIO提出反诉,称GIO侵犯了他们的专利或其他知识产权,此外还会提出反诉,称GIO的知识产权无效或不可执行,或两者兼而有之。在任何侵犯或盗用知识产权的诉讼中,存在这样一种风险,即法院将裁定GIO的知识产权全部或部分无效或不可执行,并且GIO无权阻止另一方使用该发明或其他有争议的知识产权。还有一种风险是,即使此类知识产权的有效性得到维护,法院也会狭义地解释知识产权的主张,或者以GIO的专利主张不涵盖该发明或另一方不侵犯GIO的知识产权为由,判定GIO无权阻止另一方使用该发明或争议知识产权。在涉及GIO知识产权的诉讼或程序中出现不利结果,可能会限制GIO对这些当事人或其他竞争者主张其知识产权的能力,并可能限制或阻止GIO排除第三方制造和销售类似或竞争性待遇的能力。上述任何事件都可能对GIO具有竞争力的业务地位、业务前景和财务状况产生不利影响。同样,如果GIO主张商标侵权,法院可以裁定GIO主张的商标无效或不可执行,或者GIO主张商标侵权的当事人对有关商标享有优先权利。在这种情况下,GIO最终可能被迫停止使用此类商标。
106
即使GIO确立了侵权或挪用,法院也可以决定不对进一步的侵权活动发出禁制令,而只判给金钱损失,这可能是适当的补救办法,也可能不是。此外,由于知识产权诉讼需要大量的发现,GIO的一些机密信息可能会因诉讼期间的披露而受到损害。还可以公开宣布听讯、动议或其他临时程序或事态发展的结果。如果证券分析师或投资者认为这些结果是负面的,可能会对GIO普通股的股价产生重大不利影响。此外,不能保证GIO将有足够的财政或其他资源来提出和追究此类侵权索赔,这些索赔通常会持续数年才能结案。即使GIO最终在这类诉讼中胜诉,这类诉讼的金钱成本以及转移GIO管理层和科研人员的注意力,也可能超过GIO从诉讼中获得的任何好处。上述任何情况都可能对GIO的业务、财务状况、经营业绩和前景产生重大不利影响。
GIO可能无法在全球范围内保护其知识产权。
在全球所有国家就GIO的治疗方案提交、起诉、维护、捍卫和执行知识产权的成本将高得令人望而却步,而且在美国以外的一些国家,GIO的知识产权可能没有美国那么广泛。此外,一些外国的法律对知识产权的保护程度不及美国的联邦和州法律。因此,GIO可能无法阻止第三方在美国以外的所有国家实施GIO的发明,或阻止第三方在美国或其他司法管辖区销售或进口使用GIO的发明制造的治疗。竞争对手可以在GIO未获得知识产权保护的司法管辖区使用GIO的技术开发自己的产品,也可以向GIO拥有知识产权保护的地区出口其他侵权产品,但执法权没有美国那么强。这些产品可能会与GIO的Treatments竞争,而GIO的知识产权可能无法有效或足以阻止它们参与竞争。
许多公司在保护和捍卫外国司法管辖区的知识产权方面遇到重大问题。一些国家的法律制度不赞成实施知识产权保护,这可能使GIO难以从总体上制止对其知识产权的侵犯。在外国司法管辖区强制执行GIO知识产权的程序可能会导致巨额成本,并转移GIO的努力和注意力,使其业务的其他方面,可能使GIO的知识产权面临被无效或狭义解释的风险,并可能促使第三方对GIO提出索赔。GIO可能不会在其发起的任何诉讼中胜诉,而且所判的损害赔偿或其他补救办法,如果有的话,可能不具有商业意义。
许多国家都有强制性许可法,根据这些法律,专利所有人在特定情况下可能被迫向第三方发放许可。此外,许多国家限制知识产权对政府机构或政府承包商的可执行性。在这些国家,如果知识产权受到侵犯,或者如果GIO被迫向第三方发放许可证,GIO可能有有限的补救办法,这可能会大大降低该知识产权的价值。这可能会限制GIO的潜在收入机会。因此,GIO在世界各地执行其知识产权的努力可能不足以从GIO开发或许可的知识产权中获得重大商业优势,这可能会对GIO的业务、财务状况、运营结果和前景产生不利影响。
第三方可能会声称,GIO的雇员或顾问错误地使用或披露了机密信息或盗用了商业秘密。
GIO雇佣了一些以前在大学或其他生物制药或化妆品公司工作过的人。尽管GIO将努力确保其雇员及其聘用的任何顾问在为GIO工作时不使用他人的专有信息或专门知识,但GIO可能会受到指控,称GIO或其雇员、顾问或独立承包商在无意中或以其他方式使用或披露了前雇主或其他第三方的知识产权,包括商业秘密或其他专有信息。GIO还可能被指称,GIO为保护GIO雇员或顾问的发明而提交的知识产权和申请,正当地归其前雇主或其他第三方所有。为了抗辩这些索赔,可能需要诉讼。如果GIO未能为任何此类索赔进行辩护,除了支付金钱损失外,GIO可能会失去宝贵的知识产权或人员。即使GIO成功抗辩此类索赔,诉讼也可能导致巨额成本,并分散管理层和其他员工的注意力。上述任何一项都将损害GIO的业务、财务状况、运营结果和前景。
107
与其他法律遵守事项有关的风险
如果GIO的任何一款Treatments获得批准,任何一个主要市场的不利报销决定都可能对GIO产生负面影响。此外,这种制度的不利变化(例如价格管制)可能对国内生产总值产生负面影响。
各国对新药或新疗法的上市审批、定价和报销的管理规定差异很大。在美国,最近颁布的立法可能会大幅改变审批要求,这可能会带来额外的成本,并导致获得批准的延迟。有些国家要求批准产品的销售价格,然后才能销售。在许多国家,定价审查期始于市场营销或产品许可批准之后。在一些外国市场,即使在最初批准之后,定价仍然受到政府的持续控制。因此,GIO可能会在某一特定国家获得产品的营销批准,但随后会受到价格管制的影响,从而推迟治疗的商业推出,可能会拖延很长时间,并对GIO在该国销售该产品所能产生的收入产生负面影响。不利的定价限制可能会阻碍GIO收回对一种或多种疗法的投资,即使其可能开发的任何疗法获得上市许可。
GIO能否成功地将任何产品商业化,在一定程度上也将取决于政府卫生行政部门、私人医疗保险公司和其他组织对这些疗法和相关疗法的报销额度。政府当局和第三方付款人,如私人健康保险公司和健康维护组织,决定他们将支付哪些治疗费用,并确定报销水平。美国医疗行业和其他领域的一个主要趋势是控制成本。政府当局和第三方付款人试图通过限制特定程序和治疗的覆盖面和偿还额来控制费用。
美国国会和拜登政府都表示,将继续寻求新的立法和/或行政措施来控制药品成本。美国各州也越来越多地通过立法和实施旨在控制医药产品定价的法规,包括价格或患者报销限制、折扣、对某些产品准入的限制以及营销成本披露和透明度措施,在某些情况下,还旨在鼓励从其他国家进口和批量采购。
在州一级,立法机构在通过旨在控制药品和生物制品定价的立法和实施条例方面变得越来越积极。其中一些措施包括价格或病人报销限制、折扣、对某些产品准入的限制、营销成本披露和透明度措施,在某些情况下还包括旨在鼓励从其他国家进口和批量采购的措施。此外,区域卫生保健当局和个别医院越来越多地使用招标程序来确定哪些治疗和哪些供应商将被纳入其卫生保健方案。此外,越来越多的第三方付款人要求公司从标价中给他们提供预先确定的折扣,并对医疗服务的收费提出质疑。GIO不能确定其商业化的任何产品是否能够获得偿还,如果能够获得偿还,也不能确定偿还水平。报销可能会影响GIO获得营销批准的任何治疗的需求或价格。如果无法获得补偿或只能在有限的水平上获得补偿,GIO可能无法成功地将GIO获得营销批准的任何治疗商业化。
获得新批准的Treatment的报销可能会有很大的延迟,而且覆盖范围可能比FDA或美国以外类似监管机构批准的产品用途更有限。此外,获得报销资格并不意味着任何产品都将在所有情况下获得报销,或者按照涵盖GIO成本(包括研究、开发、制造、销售和分销)的费率获得报销。如果适用的话,新治疗方案的临时偿还水平也可能不足以支付GIO的费用,而且可能不会成为永久性的。偿还率可根据产品的使用和使用该产品的临床环境而有所不同,可根据已为较低费用治疗确定的偿还水平,并可纳入其他服务的现有付款。Treatments的净价格可能会因政府医疗保健项目或私人付款人要求的强制性折扣或回扣而降低,也可能因未来法律的放宽而降低,这些法律目前限制从可能以低于美国的价格销售的国家进口Treatments。如果GIO的任何Treatments获得批准,任何此类降低都可能对其产品的净销售额产生负面影响。
108
GIO获得上市批准的任何治疗都可能受到限制或退出市场,如果GIO未能遵守监管要求,或在药物获得批准时或如果药物出现意外问题,GIO可能会受到重大处罚。
FDA和其他监管机构密切监管Treatments的批准后营销和推广,以确保它们仅针对批准的适应症并按照批准的标签的规定进行营销。FDA和其他监管机构对制造商在标签外使用方面的沟通施加了严格的限制,如果GIO不针对其批准的适应症推销其Treatments,它可能会受到FDA和包括司法部在内的其他联邦和州执法机构的标签外营销执法行动的影响。违反《联邦食品、药品和化妆品法》(简称“FDCA”)和《虚假申报法》(包括《虚假申报法》)等与Treatments的推广和广告有关的法规,也可能导致对违反联邦和州医疗欺诈和滥用法律以及州消费者保护法的调查或指控。
此外,以后发现GIO的Treatments、第三方制造商或制造工艺存在以前未知的问题,或未能遵守监管要求,可能会产生各种结果,包括:
| ● | 对这类治疗、制造商或制造工艺的限制; |
| ● | 对一种治疗的标签或销售的限制; |
| ● | 对一种治疗的分发或使用的限制; |
| ● | 进行上市后临床试验的要求; |
| ● | 收到警告或无标题信件; |
| ● | 从市场上撤出治疗; |
| ● | 拒绝批准GIO提交的待决申请或对已批准申请的补充; |
| ● | 召回治疗; |
| ● | 罚款、恢复原状或返还利润或收入; |
| ● | 暂停或撤销上市批准; |
| ● | 暂停任何正在进行的临床试验; |
| ● | 拒绝允许进口或出口GIO’s Treatments; |
| ● | 产品扣押;和 |
| ● | 强制令或施加民事或刑事惩罚。 |
政府对涉嫌违法行为的任何调查都可能要求GIO花费大量时间和资源作出回应,并可能产生负面宣传。上述任何事件或处罚的发生可能会阻碍GIO将其开发的任何Treatments商业化的能力,并对其业务、财务状况、运营结果和前景产生不利影响。
此外,如果GIO的任何一款Treatments获得上市许可,FDA可能会要求其采用风险评估和缓解策略,以确保其收益大于风险,其中可能包括一份概述产品风险的产品指南,以分发给患者,以及一份与医疗从业者的沟通计划。此外,如果GIO或其他机构后来发现其任何治疗方法引起的不良副作用,可能会导致若干潜在的重大负面后果,包括:
| ● | 监管机构可暂停或撤销对此类候选产品的批准; |
109
| ● | 监管当局可要求在标签上附加警告; |
| ● | 可能要求GIO改变这种治疗的管理方式或进行额外的临床试验; |
| ● | GIO可能会被起诉,并为对患者造成的伤害承担责任;以及 |
| ● | GIO的声誉可能会受损。 |
GIO与包括医生在内的医疗服务提供者和第三方支付方的关系将受到适用的反回扣、欺诈和滥用、反贿赂和其他医疗法律法规的约束,这可能会使GIO面临刑事制裁、民事处罚、合同损害、名誉损害以及利润和未来收益减少。
GIO未来与医疗保健提供者、第三方付款人和客户的安排可能会使GIO面临广泛适用的欺诈和滥用以及其他医疗法律法规,这些法律法规可能会限制GIO研究、营销、销售和分销其获得营销批准的Treatments的业务或财务安排和关系。根据适用的联邦和州医疗保健法律和条例,包括只有在GIO已销售Treatments的情况下才适用的某些法律和条例,限制包括但不限于以下方面:
| ● | 联邦医疗保健计划《反回扣法规》,除其他外,禁止个人或实体明知而故意地直接或间接地以现金或实物形式索取、收取、提供或提供任何报酬(包括回扣、贿赂或某些回扣),以诱使或作为回报,由个人推荐购买、租赁、订购或推荐任何物品、货物、设施或服务,而这些物品、货物、设施或服务可以在联邦医疗保险和联邦医疗补助等联邦医疗保健计划下全部或部分支付。个人或实体不需要实际了解法规或违反法规的具体意图,就可以实施违规行为; |
| ● | 联邦虚假索赔,包括《虚假索赔法》,可以通过举报行动、虚假陈述和民事罚款法来执行,其中禁止任何个人或实体在知情的情况下提出或促使提出虚假或欺诈性索赔,以支付政府资金,或在知情的情况下对虚假或欺诈性索赔作出虚假记录或陈述材料,或避免、减少或隐瞒向联邦政府付款的义务。此外,政府可以断言,包括因违反美国联邦反回扣法规而产生的物品和服务在内的索赔构成《虚假索赔法》所指的虚假或欺诈性索赔; |
| ● | 1996年的联邦《健康保险流通与责任法案》(HIPAA),除其他外,该法案禁止执行或试图执行欺诈任何医疗福利计划的计划,或在提供或支付医疗福利、与医疗事项有关的项目或服务方面作出虚假、虚构或欺诈性声明。与《联邦反回扣法规》类似,一个人或实体不需要实际了解该法规或违反该法规的具体意图,就可以实施违反行为; |
| ● | 联邦虚假陈述法规,该法规禁止在提供或支付医疗福利、物品或服务时故意和故意伪造、隐瞒或掩盖重要事实,或作出任何重大虚假陈述; |
| ● | 联邦《食品、药品和化妆品法》,除其他外,对药品营销进行严格监管,禁止制造商将这类疗法用于标签外的用途,并对样品的分配进行监管; |
| ● | 联邦法律,要求制药商向政府报告某些计算出的产品价格,或向政府当局或私人实体提供某些折扣或回扣,通常作为政府医疗保健计划的补偿条件; |
| ● | 联邦《医师付款阳光法案》,该法案要求某些药品、设备、生物制剂和医疗用品的制造商每年向美国卫生与公众服务部的CMS报告与前一年向医生(定义为包括医生、牙医、验光师、足病学家和脊医)和教学医院的付款或其他价值转移有关的信息,以及由 |
110
| 医生和他们的直系亲属。从2022年开始,这类债务将包括上一年向某些其他保健专业人员提供的付款和其他价值转移,包括医生助理、执业护士、临床护士专家、执业护士麻醉师、麻醉师助理和执业护士助产士;以及 |
| ● | 类似的国家和外国法律法规,例如国家反回扣和虚假索赔法,其范围可能更广,适用于由包括私人保险公司在内的非政府第三方付款人报销的医疗项目或服务。 |
一些州的法律还要求公司遵守特定的合规标准,限制公司与医疗服务提供者之间的财务往来,或要求公司报告与向医疗服务提供者付款或营销支出有关的信息。某些州的法律还要求报告与产品定价有关的信息。此外,某些州和地方法律要求对销售代表进行登记。
确保GIO与第三方的业务安排符合适用的医疗法律和法规的努力将涉及大量成本。鉴于法律法规的广度和政府对法律法规的不断变化的解释,政府当局可能会得出结论,GIO的商业行为,包括GIO未来与医生的任何咨询委员会安排(如果有的话),可能不符合医疗法律法规,其中一些医生可以以股票或股票期权的形式获得补偿。如果GIO的运营被发现违反上述任何法律或适用于GIO的任何其他政府法规,GIO可能会受到重大处罚,包括行政、民事和刑事处罚、损害赔偿、罚款、非法所得、不得参与政府医疗保健计划,如联邦医疗保险和联邦医疗补助计划、监禁、诚信监督和报告义务、合同损害、名誉损害、利润和未来收益减少,以及GIO业务的缩减或重组,其中任何一项都可能对GIO的业务、财务状况、运营结果和前景产生不利影响。
欧洲联盟有严格的法律,规定向保健专业人员提供福利或优惠,以便诱导或鼓励、推荐、认可、购买、供应、订购或使用治疗。这些法律和相关的业务守则规定了提供款待、赞助、礼品和促销物品必须符合的规则和要求,才能被保健专业人员接受。向保健专业人员提供福利或优惠也受欧洲联盟成员国国家反贿赂法律的管辖。违反这些法律可能导致巨额罚款和监禁。
向某些欧洲联盟成员国的保健专业人员支付的款项可以公开披露。此外,与保健专业人员签订的协议往往必须事先得到保健专业人员的雇主、其主管专业组织和/或欧洲联盟各成员国的管理当局的通知和批准。欧洲联盟成员国适用的国家法律、行业守则或专业行为守则规定了这些要求。不遵守这些要求可能导致名誉风险、公开谴责、行政处罚、罚款或监禁。
医疗保健和其他改革立法,可能增加GIO和任何合作者的难度和成本GIO可能必须获得营销批准和商业化其治疗GIO可能开发和影响价格GIO,或他们,可能获得。
在美国和一些外国司法管辖区,已经并将继续努力实施有关医疗体系的立法和监管改革。这些变化可能会阻止或延迟GIO可能开发、限制或监管批准后活动的Treatments的上市批准,并影响GIO以盈利方式销售GIO获得上市批准的任何Treatments的能力。尽管GIO无法预测哪些医疗或其他改革努力会取得成功,但这些努力可能会导致更严格的覆盖标准,给GIO或GIO未来的合作者获得任何批准的治疗方案的价格带来额外的下行压力,或者产生其他可能对GIO实现或保持盈利能力产生不利影响的后果。
在美国国内,联邦政府和各州积极推行医疗改革,ACA的通过和正在进行的修改或废除该立法的努力就证明了这一点。《ACA》极大地改变了政府和私营保险公司为医疗保健提供资金的方式,并包含了一些影响药物治疗的覆盖范围和报销和/或可能减少对治疗的需求的条款。医疗改革的其他方面,如扩大政府执法权力和提高标准,可能会增加与合规相关的成本,也可能影响GIO的业务。目前存在并可能继续存在司法挑战,包括美国的审查
111
最高法院。GIO无法预测ACA或其他联邦和州改革努力的最终内容、时间或效果。无法保证联邦或州的医疗改革不会对GIO未来的业务和财务业绩产生不利影响,GIO也无法预测未来与医疗改革相关的联邦或州立法、司法或行政改革将如何影响GIO的业务。
联邦和州政府对实施成本控制计划以限制政府支付的医疗费用的增长表现出了极大的兴趣,这些计划包括价格控制、免除联邦医疗补助药品返还法的要求、限制报销以及要求用非专利药代替品牌处方药。私营部门还试图通过限制医疗保险范围或报销或要求治疗折扣和回扣来控制医疗费用。GIO无法预测未来可能会颁布哪些与医疗行业或第三方保险和报销相关的额外立法、法规或政策,或者这些立法、法规或政策会对GIO的业务产生什么影响。任何成本控制措施都可能显著降低GIO为其潜在治疗方案确定的可用覆盖范围和价格,这将对GIO W的净收入和经营业绩产生不利影响。
已提出立法和监管建议,以扩大批准后的要求,并限制生物技术治疗的销售和促销活动。GIO不能确定是否会颁布更多的立法变化,或者FDA对生物治疗的法规、指导或解释是否会改变,或者这些变化对GIO的治疗的上市许可(如果有的话)会产生什么影响。此外,美国国会加强对FDA审批和决策过程的审查,可能会严重延迟或阻止GIO的上市审批,并使GIO面临更严格的产品标签和上市后测试等要求。
GIO的雇员、主要调查人员、顾问和商业伙伴可能从事不当行为或其他不正当活动,包括不遵守监管标准和要求以及内幕交易。
GIO的员工、顾问和商业合作伙伴有欺诈或其他不当行为的风险,如果GIO开始临床试验,GIO的主要调查人员也有风险。这些当事方的不当行为可能包括故意不遵守FDA法规或适用于欧盟和其他司法管辖区的法规,不向FDA、EMA和其他监管机构提供准确信息,不遵守美国和国外的医疗欺诈和滥用法律法规,不准确报告财务信息或数据,或者不向GIO披露未经授权的活动。特别是,医疗保健行业的销售、营销和商业安排受到旨在防止欺诈、不当行为、回扣、自我交易和其他滥用行为的广泛法律和条例的约束。这些法律法规限制或禁止范围广泛的定价、折扣、营销和促销、销售佣金、客户激励计划和其他商业安排。此类不当行为还可能涉及不当使用在临床试验过程中获得的信息,或与FDA、EMA或其他监管机构互动,这可能导致监管制裁,并对GIO的声誉造成严重损害。GIO计划采用适用于GIO所有员工的行为准则,但并不总是能够识别和阻止员工的不当行为,GIO为发现和阻止这种行为而采取的预防措施可能无法有效控制未知或未管理的风险或损失,也无法有效保护GIO免受政府调查或因未遵守这些法律或法规而引发的其他行动或诉讼。如果针对GIO采取任何此类行动,而GIO未能成功地为自己辩护或维护自己的权利,这些行动可能会对GIO的业务、财务状况、经营业绩和前景产生重大影响,包括处以巨额罚款或其他制裁。
管理GIO未来可能开展的任何国际业务的法律和法规可能会阻止GIO在美国境外开发、制造和销售某些Treatment,并要求GIO制定和实施成本高昂的合规项目。
在GIO可能开展业务的美国以外的每个司法管辖区,GIO都可能受到众多法律和法规的约束。创建、实施和维持国际商业惯例合规方案的成本很高,而且此类方案难以执行,特别是在需要依赖第三方的情况下。
《反海外腐败法》(简称《反海外腐败法》)禁止任何美国个人或企业直接或间接向任何外国官员、政党或候选人支付、提供、授权支付或提供任何有价值的东西,目的是影响该外国实体的任何行为或决定,以协助该个人或企业获得或保留业务。《反海外腐败法》还规定,其证券在美国上市的公司有义务遵守某些会计规定,要求GIO保留准确和公平地反映公司所有交易的账簿和记录,包括国际子公司,并为国际业务设计和维持适当的内部会计控制制度。反-
112
《反海外腐败法》的贿赂条款主要由司法部执行。美国证交会负责执行《反海外腐败法》的账簿和记录条款。
同样,2010年《英国反贿赂法》对与联合王国有联系的公司和个人具有域外效力。英国《反贿赂法》禁止向公职人员、个人和组织提供引诱。遵守《反海外腐败法》和《英国反贿赂法》既昂贵又困难,尤其是在腐败是公认问题的国家。此外,《反海外腐败法》给制药业带来了特别的挑战,因为在许多国家,医院由政府运营,医生和其他医院雇员被视为外国官员。在临床试验和其他工作方面向医院支付的某些款项被认为是向政府官员支付的不当款项,并导致了《反海外腐败法》的执行行动。
各种法律、条例和行政命令还限制在美国境外使用和传播,或与某些非美国国民分享为国家安全目的分类的信息,以及某些治疗和与这些治疗有关的技术数据。GIO在美国以外的扩张将需要GIO投入更多的资源来遵守这些法律,而这些法律可能会阻止GIO在美国境外开发、制造或销售某些Treatments,这可能会限制GIO的增长潜力并增加GIO的开发成本。如果不遵守有关国际商业惯例的法律,可能会造成重大处罚,包括中止或禁止政府订约。违反《反海外腐败法》可能导致重大的民事和刑事处罚。仅根据《反海外腐败法》提出的起诉就可能导致暂停与美国政府做生意的权利,直到未决的索赔得到解决。对违反《反海外腐败法》的定罪可导致长期丧失作为政府承包商的资格。由于GIO未能履行国际商业惯例相关法律规定的任何义务而导致政府合同或关系终止,将对GIO的运营产生负面影响,并损害GIO的声誉和获取政府合同的能力。美国证交会还可能因违反《反海外腐败法》的会计规定而暂停或禁止发行人在美国交易所交易证券。
遵守全球隐私和数据安全要求可能会给GIO带来额外的成本和责任,或抑制其在全球收集和处理数据的能力,如果不遵守这些要求,可能会受到巨额罚款和处罚,这可能对其业务、财务状况或经营业绩产生重大不利影响。
世界各地收集、使用、保障、分享、转移和其他处理信息的监管框架正在迅速演变,而且在可预见的将来很可能仍然不确定。在全球范围内,GIO将开展业务的几乎每个司法管辖区都建立了自己的数据安全和隐私框架,必须遵守这些框架。例如,收集、使用、披露、转移或以其他方式处理有关欧盟个人的个人数据,包括个人健康数据,受《欧盟一般数据保护条例》(GDPR)的约束,该条例于2018年5月在欧洲经济区(EEA)的所有成员国生效。GDPR的范围很广,对处理个人数据的公司提出了许多要求,包括处理健康和其他敏感数据、获得个人数据所涉及的个人的同意、向个人提供有关数据处理活动的信息、实施保护措施以保护个人数据的安全和机密性、提供数据泄露通知,以及在聘请第三方处理者时采取某些措施。GDPR扩大了GIO在欧洲经济区进行的临床试验的义务,扩大了个人数据的定义,将编码数据包括在内,并要求改变知情同意的做法,并为临床试验对象和研究人员提供更详细的通知。此外,GDPR对将个人数据转移到包括美国在内的欧盟以外国家实施了严格的规定,因此加强了对位于欧洲经济区的临床试验站点应适用于将个人数据从此类站点转移到被认为缺乏足够数据保护的国家(如美国)的审查。GDPR还允许数据保护机构要求销毁不当收集或使用的个人信息,并/或对违反GDPR的行为处以高额罚款,罚款金额最高可达全球收入的4%或2000万欧元,以金额较高者为准。GDPR还赋予数据主体和消费者协会向监管机构投诉、寻求司法补救、并就违反GDPR造成的损害获得赔偿的私人诉讼权。此外,GDPR规定,欧洲联盟成员国可以制定自己的进一步法律和条例,限制处理个人数据,包括基因、生物特征或健康数据。
美国已采取或正在采取类似行动。有各种各样的数据保护法可能适用于GIO未来的活动,州和联邦两级的执法机构也有各种各样的执法机构,可以根据一般的消费者保护法对公司的隐私和数据安全问题进行审查。联邦贸易委员会和州检察长都在积极审查对消费者的隐私和数据安全保护。州和联邦两级也在考虑制定新的法律。例如,2020年1月1日生效的《加州消费者隐私法》正在产生与GDPR所产生的风险和义务类似的风险和义务,尽管《加州消费者隐私法》确实豁免了作为临床试验的一部分而收集的某些信息,这些信息受《联邦保护人体受试者政策》的约束。
113
共同规则)。2020年3月,加利福尼亚州总检察长提出了不同版本的配套法规草案,但尚未最终确定。尽管法规迟迟未获通过,加州总检察长还是从2020年7月1日开始对违规者采取执法行动。其他许多州也在考虑类似的立法。联邦一级也采取了一系列广泛的立法措施。因此,不遵守关于个人信息隐私和安全的联邦和州法律(现行法律和未来立法)可能会使GIO面临此类法律规定的罚款和处罚。还有与这些法律和个人数据的整体保护有关的消费者集体诉讼的威胁。即使GIO没有被认定违反了这些法律,政府对这些问题的调查通常需要花费大量资源,并产生负面宣传,这可能会损害其声誉和业务。
鉴于数据保护义务变化的广度和深度,准备和遵守这些要求是严格和耗时的,将需要大量资源和审查GIO的技术、系统和做法,以及处理或转移在欧盟收集的个人数据的任何第三方合作者、服务提供商、承包商或顾问的技术、系统和做法。GDPR以及与加强保护某些类型的敏感数据(如医疗数据或GIO未来临床试验中的其他个人信息)相关的法律或法规的其他变化,可能要求GIO改变其商业惯例并建立额外的合规机制,可能会中断或延迟其开发、监管和商业化活动,增加其经营成本,并可能导致政府执法行动、私人诉讼以及对其的巨额罚款和处罚,并可能对其业务、财务状况或经营业绩产生重大不利影响。
GIO或GIO的合作伙伴可能受到与数据隐私和安全相关的严格的隐私法、信息安全法、法规、政策和合同义务的约束,此类法律、法规、政策或其解释方式的变化或合同义务的变化可能对GIO的业务产生不利影响。
美国有许多联邦和州数据隐私和保护法律法规适用于个人识别信息的收集、传输、处理、存储和使用,除其他外,这些法律法规对个人信息的隐私、安全和传输提出了某些要求。隐私和数据保护的立法和监管环境在世界各地的司法管辖区不断变化,人们越来越关注可能影响GIO业务的隐私和数据保护问题。如果不遵守这些法律法规,可能会导致对GIO的执法行动,包括罚款、监禁公司官员和公开谴责、受影响个人要求赔偿损失、损害GIO的声誉和商誉损失,其中任何一项都可能对GIO的业务、财务状况、经营业绩或前景产生重大不利影响。
如果GIO无法妥善保护GIO拥有的健康相关信息或其他敏感或机密信息的隐私和安全,GIO可能被认定违反了合同。此外,如果GIO不遵守适用的隐私法,包括适用的HIPAA隐私和安全标准,GIO可能面临重大的行政、民事和刑事处罚。执法活动还可能造成财务责任和名誉损害,对这种执法活动的反应可能消耗大量内部资源。此外,州检察长有权提起民事诉讼,寻求禁令或损害赔偿,以应对威胁到州居民隐私的侵权行为。
与员工事务、管理增长和信息技术相关的风险
如果GIO失去关键管理人员,或者未能招聘更多高技能人员,GIO开发、识别和开发新一代或下一代Treatments的能力将受到损害,这可能导致开发过程延迟,失去市场机会,降低GIO的竞争力,并对GIO的业务、财务状况和经营业绩产生重大不利影响。
GIO能否在竞争激烈的生物技术和制药行业展开竞争,取决于GIO能否吸引和留住高素质的管理、科学和医疗人才。GIO高度依赖其管理层,特别是首席执行官和首席科学官、执行团队成员以及关键的科学和医疗人员雇员。如果失去GIO的任何高管、关键员工、科学和医疗顾问的服务,以及GIO无法找到合适的替代者,可能会导致产品开发的延迟,并损害GIO的业务。
114
GIO市场上对高技能人才的竞争非常激烈,这可能会限制GIO以可接受的条件聘用和留住高素质人才的能力,或者根本无法做到这一点。
尽管GIO努力留住有价值的员工,但GIO管理、科学和开发团队的成员可能会在短时间内终止与GIO的雇佣关系。尽管GIO计划与其关键员工签订雇佣协议,并将与其首席执行官和首席科学官签订非竞争协议,但这些协议可能会规定随意雇佣,这意味着GIO的一些员工可以随时离职,无论是否通知。目前,GIO没有为关键员工或GIO其他员工的生命投保“关键人物”保险。GIO的成功还取决于GIO吸引、留住和激励高技能的初级、中级和高级管理人员以及初级、中级和高级科学和医疗人员的能力。
GIO及其管理层在运营上市公司方面的记录有限。预期商业计划的运营执行失败可能会对GIO的商业前景产生重大影响。此外,如果GIO无法吸引和留住高素质的人才,它可能无法成功实施其业务战略。
GIO的管理团队运营上市公司的经验有限,这可能会引发对GIO商业前景的猜测和不确定性,并可能导致或导致:
| ● | GIO业务中断或员工和管理层分心; |
| ● | 招聘、聘用、激励和留住有才能和有技能的人才方面的困难; |
| ● | 股票价格波动;和 |
| ● | 谈判、维持或完善商业或战略关系或交易的困难。 |
如果GIO无法降低这些风险,或无法吸引和留住高素质人才,其收入、经营业绩和财务状况可能会受到不利影响。
GIO将需要扩大其组织的规模,而GIO在管理这种增长方面可能会遇到困难。
截至2023年5月1日,GIO只有两名员工,帕特尔先生和斯里瓦斯塔瓦博士。随着GIO的开发、制造和商业化计划和战略的发展,以及GIO转型为上市公司,GIO预计需要并正在积极招聘更多的管理、运营、销售、营销、财务和其他人员。未来的增长将给管理层成员带来重大的额外责任,包括:
| ● | 确定、征聘、整合、维持和激励更多的雇员; |
| ● | 有效管理GIO的内部开发工作,包括GIO治疗的临床、FDA和国际监管审查程序,同时遵守GIO对承包商和其他第三方的合同义务;以及 |
| ● | 改善GIO的运营、财务和管理控制、报告系统和程序。 |
GIO未来的财务表现及其将Treatments商业化的能力,在一定程度上将取决于其有效管理未来增长的能力,而其管理层可能也不得不将不成比例的时间用于管理这些增长活动。
GIO将在很大程度上依赖某些独立组织、顾问和顾问来提供某些服务,包括监管审批、临床管理和生产的几乎所有方面。GIO无法向您保证,独立组织、顾问和顾问的服务将在需要时及时提供给GIO,或者GIO能够找到合格的替代者。此外,如果GIO无法有效管理其外包活动,或者顾问提供的服务的质量或准确性因任何原因受到损害,GIO的临床试验可能会被延长、延迟或终止,GIO可能无法获得监管部门对其Treatments的批准或以其他方式推进其业务。GIO不能向你保证,它将能够以经济上合理的条件管理其现有的顾问或找到其他有能力的外部承包商和顾问,或者根本不能保证。如果GIO不能通过雇用新雇员和扩大其顾问和承包商小组来有效地扩大其组织,或者如果GIO不能有效地建造新设施以适应这种扩大,GIO可能不
115
能够成功地执行其治疗的进一步开发和商业化所需的任务,因此可能无法实现其研究、开发和商业化目标。
GIO的保单可能不足,可能会使GIO面临无法挽回的风险。
GIO有有限的董事和高级职员保险和商业保险政策。任何重大保险索赔都将对GIO的业务、财务状况和经营业绩产生重大不利影响。保险的可获得性、保险条款和定价继续随市场情况而变化。GIO努力为GIO识别的可保风险获得适当的保险;然而,GIO可能无法正确预测或量化可保风险;GIO可能无法获得适当的保险;由于GIO打算承保可能发生的可保事件,保险公司可能不会做出回应。GIO观察到,几乎所有传统企业保险领域的保险市场状况都在迅速变化。这种情况导致了更高的保费成本、更高的保单免赔额和更低的承保限额。对于某些风险,由于成本或可用性的原因,GIO可能没有或维持保险范围。
GIO的内部计算机系统,或其第三方供应商、合作者或其他承包商或顾问的系统,可能出现故障或遭受安全漏洞,这可能导致其产品开发计划的重大中断,危及与其业务相关的敏感信息,或阻止GIO访问关键信息,从而可能使其承担责任或以其他方式对其业务产生不利影响。
GIO未来的内部计算机系统,以及GIO未来的第三方供应商、合作者和其他承包商或顾问的内部计算机系统,可能容易受到计算机病毒、计算机黑客、恶意代码、员工盗窃或滥用、拒绝服务攻击、复杂的民族国家和民族国家支持的行为者、未经授权的访问、自然灾害、恐怖主义、战争、电信和电力故障的破坏或中断。虽然GIO将寻求保护其信息技术系统不受系统故障、事故和安全漏洞的影响,但如果发生此类事件并导致GIO的运营中断,可能会导致GIO的开发程序和业务运营中断,无论是由于GIO的商业机密或其他专有信息的丢失,还是其他中断。例如,未来临床试验数据的丢失可能会导致GIO的监管审批工作延迟,并显著增加GIO恢复或复制数据的成本。如果GIO的信息系统或数据遭受重大网络安全破坏,与调查、补救和可能向对应方和数据主体通报破坏行为有关的费用可能是巨大的。此外,GIO的补救努力可能不会成功。如果GIO不分配和有效管理必要的资源,以建立和维持适当的技术和网络安全基础设施,GIO可能会遭受重大的业务中断,包括交易错误、供应链或制造中断、处理效率低下、数据丢失或知识产权或其他专有信息的丢失或损坏。
尽管GIO计划采取措施,帮助保护机密信息和其他敏感信息不受未经授权的访问或泄露,但GIO的信息技术和基础设施可能容易受到黑客或病毒的攻击、故障或第三方行为、员工疏忽或错误、渎职或其他事件或中断造成的破坏。例如,GIO可能成为钓鱼攻击的目标,目的是获取有关GIO员工的机密信息。此外,虽然GIO计划实施数据隐私和安全措施,以努力遵守与隐私和数据保护有关的适用法律和条例,但某些与健康有关的信息和其他个人信息或机密信息可能会由第三方传送给GIO,而第三方可能没有实施适当的安全和隐私措施,与隐私和数据保护有关的法律、规则和条例也有可能,或者信息安全的解释和应用方式可能与GIO的做法或向GIO传输健康相关信息和其他个人信息或机密信息的第三方的做法不一致。
如果GIO或这些第三方被发现违反了这些法律、规则或条例,或者任何中断或安全漏洞导致GIO或GIO的第三方供应商、合作者或其他承包商或顾问的数据或应用程序丢失或损坏,或者机密或专有信息的不当披露,GIO可能会承担包括诉讼风险、罚款和罚款在内的责任,GIO可能会成为监管行动或调查的对象,GIO的竞争地位可能会受到损害,GIO的Treatments的进一步开发和商业化可能会被推迟。上述任何一项都可能对GIO的业务、财务状况、经营业绩或前景产生重大不利影响。
116
不稳定的市场和经济状况可能会对GIO的业务、财务状况和股价产生严重的不利影响。
正如广泛报道的那样,由于新冠疫情的影响,全球信贷和金融市场在过去几年经历了波动和混乱,包括流动性和信贷供应严重减少、消费者信心下降、经济增长下降、利率上升、失业率上升以及经济稳定的不确定性。不能保证信贷和金融市场的进一步恶化以及对经济状况的信心不会发生。GIO的总体业务战略可能受到任何此类经济衰退、动荡的商业环境或持续的不可预测和不稳定的市场状况的不利影响。如果当前的股票和信贷市场恶化,可能会使任何必要的债务或股票融资变得更加困难、成本更高、更具稀释性。如果不能及时以优惠条件获得任何必要的融资,可能会对GIO的增长战略、财务业绩和股价产生重大不利影响,并可能要求GIO推迟或放弃临床开发计划。
117
精选历史财务数据
下表列出了截至2022年12月31日、2022年12月31日和2021年12月31日止年度ACIC从本委托书/招股说明书其他部分所载ACIC已审计财务报表中选定的历史财务信息。
下文所列的财务数据应与“ACIC管理层对财务状况和经营成果的讨论和分析”以及本代理声明/招股说明书其他部分所载的财务报表及其附注一并阅读,并以此为限。ACIC的财务报表是按照美国公认会计原则编制和列报的。
|
年终 |
|
期间 |
||||
损益表数据: |
|||||||
业务损失 |
$ |
(1,203,615) |
$ |
(234,315) |
|||
净收入 |
$ |
6,582,898 |
$ |
486,473 |
|||
加权平均A类流通股,基本 |
16,730,842 |
2,569,149 |
|||||
A类普通股基本净收入 |
$ |
0.31 |
$ |
0.08 |
|||
加权平均B类流通股,基本 |
4,312,500 |
3,833,777 |
|||||
已发行B类普通股的基本净收入 |
$ |
0.31 |
$ |
0.08 |
|||
加权平均A类流通股,稀释 |
16,730,842 |
2,569,149 |
|||||
A类普通股每股摊薄净收益 |
$ |
0.31 |
$ |
0.07 |
|||
加权平均B类流通股,稀释 |
4,312,500 |
4,312,500 |
|||||
B类普通股的稀释净收益 |
$ |
0.31 |
$ |
0.07 |
|||
|
12月31日, |
|
12月31日, |
||||
2022 |
2021 |
||||||
资产负债表数据: |
|||||||
信托账户中持有的现金和有价证券 |
$ |
16,182,549 |
$ |
175,952,082 |
|||
总资产 |
$ |
17,454,016 |
$ |
177,114,952 |
|||
负债总额 |
$ |
13,734,638 |
$ |
17,846,943 |
|||
可能赎回的A类普通股 |
$ |
15,381,820 |
$ |
175,950,000 |
|||
股东赤字总额 |
$ |
(11,662,442) |
$ |
(16,681,991) |
|||
118
未经审计的合并财务报表摘要
以下未经审计的简明合并财务数据摘要(“备考资料摘要”)适用于业务合并所设想的交易(“交易”)。根据美国公认会计原则,该业务合并将作为反向合并入账。在这种会计方法下,出于财务报告目的,ACIC将被视为“被收购”公司,而GIO将成为会计“收购方”。
截至2022年12月31日的未经审计的简明合并资产负债表摘要使这些交易生效,就好像它们发生在2022年12月31日一样。截至2022年12月31日止年度未经审计的简明合并经营报表摘要使这些交易生效,就好像它们发生在2022年1月1日一样。
本报告概要资料源自本委托书/招股说明书中题为“未经审计的备考简明合并财务报表”的一节中包含的更详细的未经审计的备考简明合并财务信息,并应与其一并阅读。未经审计的备考简明合并财务信息以本代理声明/招股说明书所载适用期间的历史财务报表及ACIC和GIO的相关说明为基础,并应与之一并阅读。
临时形式资料摘要仅供参考,并不一定表明如果交易在所示日期完成,合并后公司的财务状况或业务结果实际上会如何。此外,未经审计的简明合并财务报表不一定反映如果业务合并在所示日期发生,合并后公司的财务状况或业务结果会是什么情况。未经审计的简明合并财务报表也可能无助于预测合并后公司未来的财务状况和经营成果。由于各种因素,实际财务状况和业务结果可能与本文所反映的预计数额有很大差异。未经审计的备考简明合并财务报表仅供说明之用。
GIO的历史财务报表是按照美国公认会计原则编制的,其功能和列报货币为英镑(“GBP”)。ACIC的历史财务报表是按照美国公认会计原则编制的,其功能和列报货币为美元(“USD”)。GIO的财务报表已换算成美元,以便获得形式上的合并财务信息。
未经审计的简明合并财务信息是根据以下关于ACIC A类普通股可能赎回为现金的假设编制的:
| ● | 假设没有赎回:本演示文稿假定ACIC的任何公众股东均不对其公众股份行使赎回权。 |
119
| ● | 假设BCA最大赎回:这一列报假定:(一)326881股公众股赎回,赎回付款总额为340万美元,假定根据截至2023年4月30日信托账户的资金计算的每股赎回价格为10.47美元;(二)如果ACIC在收盘时没有现金或现金等价物,拟议的业务合并将不会完成,包括信托账户中的剩余资金(在完成和支付赎回款项后)和任何交易融资的收益,至少相当于在交易结束时支付ACIC和GIO的估计交易费用和负债所需的数额费用条件,”如下文进一步描述)。由于ACIC的所有Insiders在ACIC IPO时都放弃了赎回权,本演示文稿中只反映了公众股东的赎回。这一设想方案包括“无赎回”设想方案中所载的所有调整,并提出额外的调整,以反映《巴塞尔公约》最大赎回的影响,同时考虑到费用条件。“BCA最大赎回情形”(i)假设NTA提案在特别会议上获得ACIC股东的批准,并且(ii)代表在满足费用条件的情况下可赎回的最大公众股份数量;但是,前提是根据业务合并协议的条款,费用条件不是完成交易的合同条件,并且业务合并可以在不满足费用条件的情况下按照合同交易条款完成。如果企业合并在费用条件未得到满足的情况下完成(或者,如果估计的交易费用或任何交易融资的收益(如果有的话)导致在截止日期的费用条件与本BCA最大赎回情景演示文稿中包含的假设不同),最多可赎回“BCA最大赎回情景”中所反映的1175322股公众股票。 |
下表列出了合并后公司在交易结束后的形式上的股份所有权,假设分别为“无赎回情形”和“BCA最大赎回情形”:
|
无 |
|
BCA |
|
GIO卖家 |
23,568,155 |
23,568,155 |
||
ACIC公众股东 |
1,502,203 |
1,175,322 |
||
赞助商 |
4,312,500 |
4,312,500 |
||
合计 |
29,382,858 |
29,055,977 |
下表列出了来自未经审计的备考简明合并资产负债表和未经审计的备考简明合并业务报表的汇总数据。截至2022年12月31日的未经审计的简明合并资产负债表摘要使这些交易生效,就好像它们发生在2022年12月31日一样。截至2022年12月31日止年度未经审计的简明合并经营报表摘要使这些交易生效,就好像它们发生在2022年1月1日一样。
预估合并 |
||||||
|
无 |
|
BCA |
|||
截至2022年12月31日止年度未经审计的合并报表数据摘要 |
||||||
净收入 |
$ |
2,638,674 |
$ |
2,638,674 |
||
每股净收益----基本和稀释 |
$ |
0.09 |
$ |
0.09 |
||
加权平均已发行股份----基本和稀释 |
29,382,858 |
29,055,977 |
||||
截至2022年12月31日未经审计的备考简明合并资产负债表数据摘要 |
||||||
总资产 |
$ |
4,512,077 |
$ |
1,088,992 |
||
负债总额 |
$ |
3,545,936 |
$ |
3,545,936 |
||
股本总额(赤字) |
$ |
966,141 |
$ |
(2,456,943) |
||
120
股东特别会议
一般
ACIC向其股东提供这份代理声明/招股说明书,作为ACIC董事会征集代理的一部分,供定于2023年[·]举行的特别会议及其任何休会期间使用。本委托书/招股说明书将于2023年[·]前后提交给ACIC的股东,与对本委托书/招股说明书中所述提案的投票有关。这份代理声明/招股说明书向ACIC的股东提供了他们需要知道的信息,以便能够投票或指示他们在特别会议上投票。
特别会议的日期、时间和地点
特别会议将于美国东部时间2023年[·]上午[·]在https://www.cstproxy.com/[·]通过网络直播举行,审议并表决将提交特别会议的各项提案,包括必要或可取的休会提案。
可通过以下网址访问特别会议:https://www.cstproxy.com/[·],在那里你可以收听现场会议并在会议期间投票。请注意,你只能通过远程通讯方式参加特别会议。请出示你的控制号码,号码可在你的代理卡上找到,以便参加特别会议。
登记参加特别会议
如果你是注册股东,你收到了大陆集团的代理卡。该表单包含有关如何参加虚拟特别会议的说明,包括URL地址以及您的控制号码。你需要你的控制号码才能进入。如果您没有自己的控制号码,请致电917-262-2373与大陆集团联系,或发送电子邮件至proxy@continentalstock.com。
您可以预先登记参加2023年[·]美国东部时间上午[·]开始的虚拟会议。在浏览器中输入URL地址https://www.cstproxy.com/[·],输入控制号、姓名和电子邮件地址。一旦你预先登记,你就可以投票你的股份。在特别会议开始时,你需要使用你的控制号码重新登录,如果你在特别会议期间投票,也会提示你输入你的控制号码。
通过银行、经纪商或其他代名人拥有其投资的实益投资者需要联系大陆集团以获得一个控制号码。如果您打算在特别会议上投票,您需要有您的银行、经纪人或其他代名人的法定代理人,或者如果您想加入而不是投票,大陆集团将向您发出带有所有权证明的客人控制号码。
请在特别会议召开前最多留出72小时处理你的控制号码。
如果您没有互联网功能,您只能通过在美国和加拿大境内拨打[·],在美国和加拿大境外拨打[·]收听特别会议(标准费率适用),提示输入密码[·]。这是只听,你将不能投票或输入问题在会议期间。
特别会议的目的
在特别会议上,ACIC要求其普通股股东考虑并投票表决:
| ● | 业务合并提案。本代理声明/招股章程附有业务合并协议副本,作为附件A. |
| ● | NTA提案。 |
| ● | 宪章提案。建议章程于业务合并完成后生效的格式附于本代理声明/招股章程内,作为附件B. |
| ● | 组织文件提案。 |
121
| ● | 奖励计划提案。激励计划于业务合并完成后生效的表格附于本委托说明书/招股章程内,作为附件D. |
| ● | 董事选举提案。 |
| ● | 临时提案,如果在特别会议上提出。 |
行政协调会理事会关于提案的建议
ACIC董事会认为,将在特别会议上提交的企业合并提案和其他提案符合ACIC的最佳利益,并建议ACIC的股东对企业合并提案投“赞成”票,对NTA提案投“赞成”票,对章程提案投“赞成”票,对单独的组织文件提案投“赞成”票,对激励计划提案投“赞成”票,对董事选举提案投“赞成”票,如果在特别会议上提交,对休会提案投“赞成”票。
记录日期;有权投票的人
ACIC已将2023年[·]的截止日期定为确定有权获得特别会议通知并出席特别会议并在会上投票的股东的记录日期。截至2023年[·]日收盘时,共有5,814,703股普通股流通在外,有权投票。每股普通股有权投一票。
法定人数
代表有权在特别会议上投票的所有未发行股票的多数表决权的已发行和未发行的ACIC普通股的持有人亲自或由代理人代表,即构成法定人数。在未达到法定人数的情况下,会议主席有权根据《现行宪章》的规定休会。
弃权和经纪人不投票
对于除本委托书/招股说明书中的董事选举提案以外的每项提案,您可以投“赞成”、“反对”或“弃权”票。对于董事选举建议书中所描述的董事提名人,你可以投“赞成所有人”或“保留所有人”的票,也可以拒绝就你提名的特定被提名人投票。
如果股东未交回代理卡,或未指示经纪人或其他代名人如何投票,且未亲自出席特别会议,则该股东的股份将不计算在内,以确定出席特别会议的人数是否达到法定人数。如果确定了有效的法定人数,任何此类未投票或未提供投票指示将不会影响本代理声明/招股说明书中任何其他提案的结果。
弃权票和中间人不投票,虽然为确定法定人数而被视为出席,但不计入在特别会议上所投的票。
批准须经表决
在特别会议上,每项提案均需获得以下表决:
| ● | 业务合并提案:企业合并提案要求获得在特别会议上投票的ACIC普通股多数股东的赞成票。 |
| ● | NTA提案:NTA提案必须获得作为单一类别共同投票的ACIC普通股多数股东的赞成票才能通过。 |
| ● | 宪章提案:《章程》提案必须获得持有已发行ACIC普通股多数股份的股东(包括持有B类股份多数股份的股东,作为一个单独类别共同投票)的赞成票。 |
122
| ● | 组织文件提案:组织文件提案,每一项都是不具约束力的咨询投票,必须得到已发行ACIC普通股多数股东的赞成票。 |
| ● | 奖励计划提案:激励计划提案要求获得在特别会议上投票的ACIC普通股多数股东的赞成票。 |
| ● | 董事选举提案:选举被提名的董事需要出席特别会议或由代理人代表出席特别会议的ACIC普通股股东的多数票。“多元化”指的是,获得“赞成”票数最多的个人当选为董事。 |
| ● | 休会提案:延期提案要求获得在特别会议上投票的ACIC普通股多数股份持有人的赞成票 |
所需提案是相互依存的。组织文件提案以业务合并提案为条件;暂停提案不以核准任何其他提案为条件。如果ACIC的股东没有在特别会议上批准每一项必要的提案,那么企业合并将无法完成。
在与2022年12月21日ACIC股东大会有关的公众股东赎回后,保荐人拥有约74.2%的ACIC普通股流通股,有权在特别会议上投票。根据内幕信息交易协议的条款,保荐人已同意将其拥有的所有ACIC股票投票支持企业合并和其他提案。根据《现行章程》所载的条款和规定,假定特别会议达到法定人数,并且保荐人按照《内幕交易协议》的要求在特别会议上投票表决其股份,即使ACIC的部分或全部公众股东不批准企业合并或其他提案,企业合并和其他提案也可以在特别会议上获得批准。
投票表决你的股份
您以您的名义持有的ACIC普通股的每一股都赋予您一票的权利。你的代理卡上显示了你所拥有的普通股的数量。如果你的股票是以“街道名称”持有的,或者是保证金或类似的账户,你应该联系你的银行、经纪人或其他代名人,以确保与你实益拥有的股票相关的投票被正确计算。有两种方法可以在特别会议上对你的普通股进行投票。
您可以通过签名并返回随附的代理卡进行投票。如果你用代理卡投票,你的“代理卡”上列着你的名字,它将按照你在代理卡上的指示对你的股票进行投票。如果你签署并交还代理卡,但没有说明如何投票,你的股份将按照ACIC董事会的建议进行投票:“赞成”企业合并提案,“赞成”NTA提案,“赞成”章程提案,“赞成”组织文件提案,“赞成”激励计划提案,“赞成”董事选举提案,如果在特别会议上提出,“赞成”休会提案。在特别会议上对某一事项进行表决后收到的选票将不计算在内。
你可以出席特别会议并在网上投票。行政协调会将通过网络直播主持特别会议。如果你以虚拟方式出席特别会议,你可以在网上提交你在特别会议上的投票,网址是:https://www.cstproxy.com/[·],在这种情况下,你以前提交的任何投票将被你在特别会议上投的票所取代。关于如何出席特别会议的进一步详情,见上文“----登记参加特别会议”。
撤销你的代理人
股东可按下述地址向ACIC首席执行官寄发一张日期较晚、已签署的代理卡,以便ACIC首席执行官在特别会议(定于2023年[·]东部时间[·]上午[·]举行)投票前收到该卡,或以虚拟方式出席特别会议并投票。股东还可以通过向ACIC的首席执行官发送撤销通知来撤销其代理权,ACIC的首席执行官必须在特别会议投票之前收到通知。然而,如果你的股票是由你的银行、经纪人或其他代名人以“街道名称”持有的,你必须联系你的银行、经纪人或其他代名人来改变你的投票。
123
谁可以回答你关于投票你的股票的问题
如果你是一名股东,对如何就你的普通股股份投票或指挥投票有任何疑问,你可以致电[·],即ACIC的代理律师[·],或[·](银行、经纪人和其他代名人)。
ACIC内部人士投票
拥有ACIC已发行和流通普通股74.2%股份的保荐人,此前已同意将其所有普通股投票支持提交给他们审批的企业合并,包括企业合并。此外,内部人士及其关联公司已同意对他们拥有的任何普通股进行投票,以支持企业合并。
赎回权
公众股东可以选择赎回其全部或部分公众股份,无论他们是否投票赞成或反对企业合并提案。
任何公众股东均可要求赎回其公众股份,其每股价格以现金支付,相当于在企业合并完成前两个营业日存入信托账户的总金额,包括先前未发放给ACIC以支付ACIC税款的资金所赚取的利息,除以当时已发行的公众股份的数量,但前提是该公众股东必须遵循本委托书/招股说明书中概述的程序(包括,对于属于ACIC单位的公众股份,ACIC单位必须首先按照本委托书/招股说明书中的描述被分离为组成部分的公众股份和认股权证),以便为该公众股东打算赎回的任何公众股份收取现金。截至2023年[·],根据信托账户在该日期持有的数额,这一数额约为每股公股[·]美元。
如果公众股东行使其赎回权,那么它将用其赎回的公众股份换取现金,并且将不再拥有这些股份。任何赎回要求一经提出,可随时撤回,直至要求赎回的截止日期,其后经ACIC同意,直至企业合并完成,或ACIC董事会确定的其他日期。持有人可通过联系转让代理提出此种请求,地址或电子邮件地址列于本代理声明/说明书中。
尽管有上述规定,公众股东,连同该公众股东的任何附属机构或与该公众股东一致行动的任何其他人,或作为一个“团体”(如《交易法》第13条所定义),将被限制赎回其公众股份,不得超过公众股份总数的15%。因此,如果公众股东单独或一致行动或作为一个集团寻求赎回超过15%的公众股份,则超过15%限制的任何此类股份将不会被赎回为现金。
ACIC的内部人士将不会直接或间接拥有任何公众股份的赎回权。
只有在以下情况下,你方有权获得赎回任何公众股份的现金:
| (a) | 持有公众股份或透过ACIC单位持有公众股份,而你在行使有关公众股份的赎回权前,选择将你的ACIC单位分为基础公众股份及公众认股权证;及 |
| (b) | 美国东部时间下午5时前,在[·]、2023年(特别会议投票前两个工作日)(或ACIC自行决定批准的较后日期),(i)向转让代理提交书面请求,要求ACIC以现金赎回您的公众股份,以及(ii)通过DTC以实物或电子方式将您的股票证书(如有)和其他赎回表格交付给转让代理。 |
ACIC单位的持有人在行使有关公众股份的赎回权之前,必须选择将基础公众股份和公开认股权证分开。持有人可以指示其银行、经纪人或其他代名人这样做,或者,如果持有人持有以自己的名义注册的ACIC单位,持有人必须直接与转让代理人联系并指示其这样做
没有按照这些程序(以实物或电子方式)投标的公众股份将不会被赎回为现金。
124
任何赎回要求一经提出,可随时撤回,直至要求赎回的截止日期,其后经ACIC同意,直至企业合并完成,或ACIC董事会确定的其他日期。持有人可以通过在本代理声明/说明书中列出的地址或电子邮件地址与转让代理联系提出此类请求。只有在要求赎回的截止日期之前,ACIC才会被要求履行这一要求。
如果企业合并因任何原因未获批准或完成,则选择行使赎回权的公众股东将无权赎回其股份。在这种情况下,ACIC将立即返还公众股东之前交付的任何股票。
公众股份于2023年[·]日的收盘价为每股[·]美元。在行使赎回权之前,股东应核实公众股份的市场价格,因为如果每股市场价格高于赎回价格,他们在公开市场出售其公众股份所获得的收益可能高于行使其赎回权所获得的收益。ACIC不能向公众股东保证,他们将能够在公开市场上出售他们的公众股份,即使每股市场价格高于上述赎回价格,因为当ACIC的股东希望出售他们的股份时,ACIC的证券可能没有足够的流动性。
评估权
ACIC的股东不享有与DGCL下的业务合并有关的评估权。
代理征集费用
ACIC代表ACIC董事会征集代理人。这一招标是通过邮件进行的,但也可以通过电话或亲自进行。ACIC及其董事、管理人员和雇员也可以亲自、通过电话或其他电子方式征集代理人。ACIC将承担招标费用。
ACIC已聘请[·]协助代理招标过程。ACIC将向该公司支付$ [·]的费用,外加自付费用。此种费用将在结账时用可用资金支付。
ACIC将要求银行、经纪商和其他机构、被提名人和受托人将代理材料转发给他们的委托人,并获得他们执行代理和投票指示的权力。ACIC将补偿他们的合理开支。
可能购买公众股份或认股权证
在特别会议之前的任何时间,在他们不知道有关ACIC或ACIC证券的任何重大非公开信息的时期内,ACIC的内部人士和GIO或他们各自的关联公司可以从投资者那里购买公众股份或公开认股权证,或者他们可以与这些投资者和其他人进行交易,为他们提供激励,以购买公众股份或投票支持企业合并提案,或撤回任何赎回请求。在这种交易中,购买公众股份的价格将不超过赎回价格。此外,根据内幕信息交易协议的条款,上述人士将放弃对其在此类交易中获得的公众股份的赎回权(如果有的话)。然而,上述人士取得的任何公众股份将不会就企业合并建议进行表决。
这种股份购买和其他交易的目的是增加完成业务合并的条件得到满足的可能性。这可能会导致我们的业务合并的完成,而这本来是不可能的。尽管截至本代理声明/招股说明书发布之日,任何此类激励措施的确切性质尚未确定,但它们可能包括但不限于保护此类投资者或持有人免受其股票价值潜在损失的安排,包括授予看跌期权。
订立任何该等奖励安排,可能对公众股份有抑制作用。例如,由于这些安排,投资者或持有者可能有能力以低于市场的价格有效购买股票,因此可能更有可能在特别会议之前或之后立即出售其所拥有的股票。
125
截至本代理声明/招股说明书之日,尚未进行过此类讨论,也未与任何此类投资者或持有人达成任何此类协议。如果订立此类安排或协议,ACIC将在特别会议之前提交一份8-K表格的当前报告,以披露上述任何人订立的任何安排或进行的重大采购。任何此类报告将包括(i)购买的公众股份的数量和购买价格;(ii)购买的目的;(iii)此类购买对企业合并交易获得批准的可能性的影响;(iv)如果不是在公开市场购买,则出售股份的证券持有人的身份或特征或卖方的性质;以及(v)ACIC收到赎回请求的公众股份的数量。
ACIC董事和管理人员的财务和个人利益的存在可能导致利益冲突,包括在决定建议股东投票支持提案时,符合ACIC及其股东最佳利益的事项与符合董事个人利益的事项之间的冲突。有关更多信息和其他风险,请参见标题为“风险因素”、“建议1:业务合并建议—— ACIC的保荐人、董事和高级管理人员及其他人员在业务合并中的权益”和“证券的实益所有权”的章节。
126
Proposal 1:The BUSINESS COMBINATION Proposal
ACIC要求其股东批准《企业合并协议》及其所设想的交易,包括企业合并。股东应仔细阅读本代理声明/招股说明书全文,以获取有关《企业合并协议》的更详细信息,该协议作为附件A附于本代理声明/招股说明书,并通过引用纳入本代理声明/招股说明书。请参阅下文题为“企业合并协议”的小节,了解更多信息和企业合并协议某些条款的摘要。我们促请你在就这项建议进行表决前,先阅读《企业合并协议》全文。
本节描述了业务合并协议的重要条款,但并不旨在描述业务合并协议的所有条款。以下摘要全文参照《企业合并协议》和《附属协议》全文加以限定。我们敦促ACIC的股东和其他利益相关方全面阅读《企业合并协议》,因为它是规范企业合并的主要法律文件。
业务合并协议载有各当事方在业务合并协议日期或其他具体日期,包括在某些情况下,在业务合并结束时彼此作出的陈述、保证和契约。这些陈述、保证和契约中所载的主张是为各当事方之间的合同目的而作出的,并受各当事方在谈判《企业合并协议》时商定的重要限制和限制的约束。企业合并协议中的陈述、保证和契约也在很大程度上受到所附披露时间表的修改,这些披露时间表不公开提交,并受制于与一般适用于股东的标准不同的合同重要性标准。披露时间表的目的是在各当事方之间分配风险,而不是将事项确定为事实。ACIC不认为披露时间表包含对投资决策具有重要意义的信息。
企业合并协议
2023年3月8日,ACIC与GIO、买方代表、卖方代表和卖方签订了业务合并协议。
根据业务合并协议,根据协议中规定的条款和条件,卖方将向ACIC出售,ACIC将向卖方购买卖方拥有的GIO的所有已发行和流通股本,以换取新发行的A类普通股,每股ACIC的面值为0.0001美元。在收盘前未转换为GIO普通股的任何GIO期权、认股权证和其他可转换证券将于收盘时终止。
根据业务合并协议的条款,ACIC在交割时向卖方交付的总对价将是ACIC A类普通股的新发行股份数量,总价值为2.50亿美元乘以百分比,等于(i)购买的股份总数除以(ii)GIO已发行和未发行的股本总数加上GIO库存中持有的股本股份数量。GIO在交割后立即以库存形式持有的任何股本股份将由GIO注销。卖方目前是企业合并协议的一方,合计持有GIO已发行和流通普通股的98.703%;其他GIO股东可在交易结束前通过在登记声明生效后签署合并协议成为企业合并协议的一方。
除了在收盘时可交付的对价外,在收盘后,如果某些指标在从生效时间开始到截止日期五周年结束的期间内得到满足,某些卖方可能有权获得最多54,000,000股乘以所购股份百分比的ACIC A类普通股的额外股份。具体来说:
| a) | 如果在盈利期内,ACIC A类普通股在主要证券交易所或证券市场的成交量加权平均交易价格在连续三十个交易日内的任何二十个交易日内高于或等于12.50美元,则盈利期卖方将有权获得总计15,000,000股盈利期股票乘以所购股份百分比; |
127
| b) | 如果在盈利期内,交易价格高于或等于15.00美元,则盈利期卖方将有权获得总计18,000,000股额外盈利期股票乘以所购股票百分比;以及 |
| c) | 如果在盈利期内的任何时间和当日,交易价格大于或等于17.50美元,则盈利卖方将有权获得总计21,000,000股额外盈利股票乘以所购股票百分比。 |
如果在盈利期内,合并后公司的控制权发生变更,据此合并后公司或其股东有权收取对价,该对价意味着A类普通股的每股价值等于或超过一个或多个触发事件所依据的交易价格,那么,在此控制权变更完成之前,(i)在相关触发事件以前未曾发生的范围内,此类相关触发事件应被视为已经发生,并且(ii)每个盈余卖方应有权根据被视为发生的适用触发事件获得其所发行的适用盈余股票数量的按比例份额。
完成业务合并的条件
企业合并协议载有完成交易的条件,包括各方的下列相互条件(除非被放弃):(一)ACIC股东对企业合并及相关交易和事项的批准;(二)根据适用的反托拉斯法,等待期届满或终止;(三)已取得或作出了所有必须从任何政府机构取得或与任何政府机构作出的同意;(四)已收到某些第三方的同意;(五)没有任何政府机构颁布、发布、颁布、执行或订立任何法律(无论是临时的,初步或永久)或当时有效的命令,其效果是使《企业合并协议》所设想的交易或协议成为非法,或以其他方式阻止或禁止其所设想的交易的完成,(六)除非股东批准对ACIC组织文件的修订以取消此项要求,ACIC将在代理声明中要求该要求批准此项交易,ACIC在企业合并完成之前或完成后拥有至少5,000,001美元的有形资产净值,(vii)ACIC通过对其组织文件的某些修订;(viii)在收盘后ACIC董事会的成员已按照《企业合并协议》的要求当选或任命;(ix)表格S-4上的登记声明(“登记声明”)已根据经修订的1933年《证券法》的规定生效;(x)在企业合并中将发行的ACIC A类普通股已在国家证券交易所上市交易。
此外,除非GIO放弃,GIO完成业务合并的义务除由ACIC交付惯常证书和其他交割交付品外,还须满足下列额外交割条件:(i)ACIC的陈述和保证在交割日和截止交割日是真实和正确的,如同在交割日作出的一样(除某些例外情况和总体的“重大不利影响”标准外),(二)ACIC在所有重大方面履行了其所有义务,并在所有重大方面遵守了其在截止日期当日或之前须履行或遵守的《企业合并协议》项下的所有协议和契诺;(三)自《企业合并协议》之日起对ACIC不存在任何重大不利影响,而该协议仍在继续且未得到修正;(四)《卖方登记权协议》的执行;(五)GIO和卖方已收到ACIC就某些ACIC公司事项提供的证书或其他确认。
除非ACIC放弃,ACIC完成业务合并的义务除GIO交付惯常证书和其他交割交付品外,还须满足以下附加交割条件:((i)GIO和卖方的陈述和保证在交割日和截止交割日是真实和正确的,如同在交割日作出的一样(除某些例外情况和总体的“重大不利影响”标准外);(ii)GIO,卖方和卖方代表已在所有重大方面履行了各自的所有义务,并在所有重大方面遵守了其在截止日期或之前将履行或遵守的《业务合并协议》项下的所有协议和契约,(iii)自《业务合并协议》签订之日起,GIO及其子公司未发生任何重大不利影响,且该重大不利影响仍在持续且未得到纠正,(四)ACIC收到GIO关于某些GIO公司事项的证书或其他确认,以及(v)GIO重组的完成,(vi)《雇佣协议》的执行,(vii)《供应协议》的执行和(viii)某些GIO合同的终止。
128
申述及保证
业务合并协议载有ACIC、GIO和卖方各自的陈述和保证,这些陈述和保证是类似交易的合理惯例,并包括某些适用的限定条件和惯例例外。此外,许多陈述和保证都受到《企业合并协议》中规定的例外或限定条件的限制,受到根据《企业合并协议》的某些披露时间表提供的信息的限制,或者受到重要性、重大不利影响或类似限定条件的限制。企业合并协议中所用的“重大不利影响”是指就任何特定的个人或实体而言,任何事实、事件、发生、变化或影响,已对(i)该个人及其附属公司作为一个整体的业务、资产、负债、经营成果、前景或状况(财务或其他方面)产生或合理预期将对(i)整体产生重大不利影响的任何事实、事件、发生、变化或影响,(ii)该人或其任何附属公司有能力及时完成业务合并协议或其作为其中一方或受其约束的附属文件所设想的交易,或履行其在该协议下的义务。
物质不利影响
许多陈述和保证是根据重要性或实质性不利影响加以限定的。企业合并协议中所用的“重大不利影响”是指,对于任何特定的人,任何事实、事件、发生、变化或影响,已经或合理预期将单独或合计对(a)该人及其子公司的整体业务、资产、负债、经营、经营成果、前景或状况(财务或其他方面)产生重大不利影响,(b)该人或其任何附属公司有能力及时完成本协议或其作为当事方或受其约束的附属文件所设想的交易,或履行其在本协议下或根据本协议承担的义务;但就上文(a)款而言,任何直接或间接可归因于、由此产生、与之有关或由此产生的变更或影响(本身或与任何其他变更或影响合并时),不应被视为构成,或在确定是否存在或可能、将会或可能已经发生重大不利影响时考虑到:(i)金融或证券市场的一般变化,或该人或其任何附属公司在其经营业务的国家或地区的一般经济或政治条件;(ii)变化,一般影响该人或其任何附属公司主要经营所在行业的条件或影响;(iii)适用法律(包括新冠疫情措施)或公认会计原则或其他适用会计原则的变更,或适用于该人及其附属公司主要经营所在行业的监管会计要求的强制性变更;(iv)天灾、恐怖主义、战争(无论是否宣示)(包括俄罗斯入侵乌克兰或任何周边国家)造成的条件,自然灾害或大流行病(包括新冠疫情)或其恶化;(v)该个人及其附属机构本身未能满足任何期间的内部或公布的预算、预测、预测或财务执行情况预测(但在确定是否已发生或合理预期会发生重大不利影响时,可考虑任何此类失败的根本原因,其程度不在本文另一例外情况所排除的范围内)和(vi)就行政协调会而言,任何赎回的完成和影响;但进一步规定,任何事件、发生、事实,上述第(i)–(iv)条所述的条件或变更,在确定是否已发生或可合理预期会发生重大不利影响时,须考虑到该等事件、发生、事实、条件或变更对该人或其任何附属公司的影响,与该人或其任何附属公司主要经营其业务的行业的其他参与者相比,具有不成比例的影响。尽管有上述规定,对于ACIC,任何赎回的金额或未能获得ACIC股东批准或赎回限制修正案的金额不应被视为对ACIC或就ACIC而言的重大不利影响。
申述、保证及契诺的存续
业务合并协议中所载各方的陈述和保证自交易结束时终止,且不在交易结束后继续有效,对于另一方的违约行为不存在赔偿权利。业务合并协议所载的各当事方的契诺和协议不在交割后继续有效,但在交割后履行的契诺和协议除外,这些契诺和协议在完全履行之前仍然有效。
各缔约方的公约
双方的相互盟约
《企业合并协议》除其他事项外,包括各方关于以下事项的习惯契约:(一)在企业合并完成之前经营各自的企业,以及努力满足完成企业合并的条件;(二)获取信息;(三)合作筹备登记
129
ACIC预计将就企业合并向SEC提交的声明,以及(iv)获得各方各自股东的所有必要批准。此外,ACIC、GIO和卖方均同意不根据《企业合并协议》中规定的习惯条款和规定招揽或进行竞争性替代交易。
GIO的某些盟约
业务合并协议还规定,在交割前,GIO应:
| ● | 尽最大努力促使Deven Patel和Anand Srivastava博士按照ACIC和GIO合理接受的条款与ACIC签订新的雇用协议就业协议"),自交易结束时起生效; |
| ● | 真诚地与ACIC以及与Deven Patel和Anand Srivastava博士有关联的实体谈判一项供应协议("供应商"),其形式和实质内容为行政协调会合理接受,自结束时起生效供应协议"),据此,供应商将在交割后四年内向GIO及其子公司提供总价值不超过1350万美元的供应商干细胞化妆品血清(在交割后立即提供价值50万美元的此类血清),价格为每单位GS的直接可变成本(不加价)加上交货成本,交付成本可在ACIC选举时以现金或合并后公司的股份支付;以及 |
| ● | 修订与GIO的知识产权及公司管理有关的若干协议公司重组”). |
ACIC的某些公约
ACIC将及时向SEC提交所有公开文件,并在所有重大方面遵守适用的证券法,并将在交易结束前就ACIC股票、公开股票和公开认股权证的上市做出商业上合理的努力。
合并后的公司和ACIC应采取一切合理和必要的行动,以满足《证券法》、《交易法》和其他适用法律在登记声明、ACIC特别会议和赎回方面的要求;
在收到证交会的登记声明“澄清”意见并经证交会宣布生效后,ACIC和GIO应在切实可行的范围内尽快将代理声明分发给ACIC的股东和GIO卖方,并据此按照DGCL的规定,在不迟于本登记声明生效后30天内召集特别会议。
除某些例外情况外,在交割前,ACIC将被允许为ACIC及其董事和高级管理人员就在生效时间或之前发生的事项获得尾部董事和高级管理人员责任保险,如果被购买,合并后的公司和存续子公司应在生效时间起六年内保持该保单的有效性。
终止
如果在2023年8月14日或根据《企业合并协议》可能延长的其他日期之前没有完成业务合并协议,则ACIC或GIO可在交易结束前的任何时间终止业务合并协议。
在某些其他惯例和有限情况下,企业合并协议也可在交易结束前的任何时间终止,除其他原因外,包括:(一)经ACIC和GIO相互书面同意,(二)由ACIC或GIO发出书面通知,如果有管辖权的政府当局发布命令或采取任何其他行动永久限制、禁止或以其他方式禁止企业合并协议所设想的交易,并且该命令或其他行动已成为最终的和不可上诉的,(三)由GIO发出书面通知,说明ACIC未纠正地违反陈述、保证,(iv)由ACIC发出书面通知,告知GIO违反业务合并协议所载的陈述、保证或契诺,而该等陈述、保证或契诺将导致相关的成交条件不获满足;(v)由ACIC发出书面通知,告知GIO在业务合并协议日期后对GIO及其附属公司产生重大不利影响,且
130
(v)如果ACIC召开股东大会批准企业合并协议和企业合并,但未获得批准,则由ACIC或GIO批准。
信托账户豁免
GIO、卖方和卖方代表一致认为,他们及其附属机构对ACIC为其公众股东持有的信托账户中的任何款项不享有任何权利、所有权、权益或任何种类的要求,并同意不对该信托账户提出任何要求(包括任何分配),并放弃任何权利。
买方代表和卖方代表
Apeiron Capital保荐人有限责任公司担任《企业合并协议》下的买方代表,并将在《企业合并协议》下的某些事项上代表合并后公司股东(GIO卖方除外)的利益,包括在交易完成后对交易所对价的任何调整的确定方面。Deven Patel担任《业务合并协议》下的卖方代表,并以该身份代表GIO卖方在《业务合并协议》下的某些事项上的利益,包括在确定交易结束后对交易所对价的任何调整方面。
管辖法律
企业合并协议受特拉华州法律管辖,双方受纽约州纽约县联邦法院和州法院(及其任何上诉法院)的专属管辖权管辖。根据《企业合并协议》发生的任何争端,除要求强制执行或临时公平救济或执行仲裁裁决外,将由美国仲裁协会在纽约州纽约县进行仲裁。
附属协定
本节说明根据《企业合并协议》订立或将要订立的某些附加协议(“附属协议”)的重要条款,但并不打算说明其中的所有条款。以下摘要全文参照每一项附属协定的全文加以限定,每一项协定的副本均作为证物附在本文件之后。促请股东和其他有关各方全文阅读这类附属协议。
投票协议
在执行和交付业务合并协议的同时,ACIC和GIO与GIO的某些股东(“GIO Insiders”)签订了投票协议(“投票协议”)。根据投票协议,GIO Insiders同意将其所有GIO普通股投票赞成《业务合并协议》、由此设想的交易以及将提交GIO股东批准的某些其他相关事项。GIO Insiders还同意采取某些其他行动来支持业务合并协议和相关交易,并且不采取会对这些GIO Insiders履行投票协议义务的能力产生不利影响的行动。投票协议还禁止GIO内部人士在投票协议日期至截止日期之间转让GIO股份,但投票协议中规定的某些允许转让除外。
锁定协议
在执行和交付《企业合并协议》的同时,GIO内部人士同意,除某些惯例例外情况外,不得(i)出借、要约、质押、抵押、担保、捐赠、转让、出售、合同出售、出售购买的任何期权或合同、购买的任何期权或出售的合同、授予购买的任何期权、权利或认股权证,或以其他方式直接或间接转让或处置ACIC A类普通股的任何股份,(ii)订立全部或部分转让给另一方的任何互换或其他安排,ACIC A类普通股所有权的任何经济后果,或(iii)公开披露上述任何一项的意图,直至交易结束一年后的日期。如果从收盘后第180天开始,ACIC A类普通股的交易价格大于或等于12.00美元,则此类限制将失效。
131
不竞争和不招标协议
在执行和交付《企业合并协议》的同时,GIO的某些股东(每个股东都是“GIO主体方”)签订了一项非竞争和非邀约协议(“非竞争和非邀约协议”),在交割时生效,根据该协议,他们同意,在交割后的三年期间,他们将不会(i)推广以干细胞为基础的献血替代品;(ii)推广以干细胞为基础的美容护肤品;(iii)经营提供抗衰老干细胞为基础的治疗的诊所(印度、墨西哥除外,哥斯达黎加和GIO主题缔约方的附属机构目前在《企业合并协议》签署之日参与此类治疗的美国城市),或(iv)参与COVID后干细胞治疗的临床试验。
卖方登记权协议
在执行和交付业务合并协议的同时,GIO Insiders签订了一份登记权协议,自交割之日起生效。根据该协议,ACIC将向GIO Insiders提供登记权,涉及(i)在交割时作为对价向GIO Insiders发行的ACIC A类普通股和(ii)他们在交割后收到的任何盈利股份。
ACIC的保荐人、董事和高级管理人员及其他人员在企业合并中的权益
在考虑ACIC董事会对企业合并投赞成票的建议时,公众股东应该意识到,除了作为股东的利益之外,ACIC的内部人士在企业合并中的利益与ACIC的公众股东的利益不同,或者除了这些利益之外。ACIC的董事在评估企业合并以及向ACIC的股东建议他们批准企业合并时,都意识到并考虑了这些利益。公众股东在决定是否批准企业合并时应考虑到这些利益。除其他外,这些利益包括:
| ● | 保荐人持有从ACIC购买的4312500股创始人股份,总价为25000美元,如果合并完成,在合并时的价值会高得多,根据ACIC普通股在2023年5月9日的收盘价10.50美元计算,在同一日期的总价值约为4530万美元。如果ACIC没有在2023年8月14日之前完成业务合并或其他初始业务合并,因此ACIC被要求清算,这些股份将一文不值,因为Founder Shares无权参与信托账户的任何赎回或清算。根据保荐人为创始人股份支付的每股0.006美元的实际购买价格与首次公开发行中每单位10.00美元的购买价格之间的差额,即使合并后公司的股价在收盘后低于首次公开发行中最初为ACIC单位支付的价格,并且ACIC公众股东在企业合并结束后经历负回报率,保荐人仍可获得正回报率; |
| ● | 保荐人以每份私人认股权证1.00美元购买的8,200,000份私人认股权证,如果不能完成业务合并,这些认股权证将一文不值(尽管私人认股权证拥有与公开认股权证持有人的权利不同的某些权利,假设私人认股权证的每份认股权证价值与2023年5月9日公开认股权证在OTCM的0.04美元收盘价相同,保荐人持有的8,200,000份私人认股权证的总价值估计约为328,000美元); |
| ● | 如果ACIC无法完成其初始业务合并,ACIC的内部人士已放弃在ACIC清算时赎回其创始人股份及其持有的任何其他普通股的权利,或从信托账户获得有关创始人股份的分配; |
| ● | 除非ACIC完成初始业务合并,否则其董事和高级管理人员将不会获得补偿,以补偿他们因业务合并而产生的任何自付费用(只要这些费用超过未存入信托账户的可用收益的数额)。截至[·],2023年,ACIC的任何董事或高级职员都没有发生任何他们预期在交易结束时得到补偿的费用; |
| ● | 继续向ACIC现任董事和高级职员提供赔偿,并在业务合并后继续提供董事和高级职员责任保险; |
132
| ● | 内部人可能被激励完成企业合并,或与不那么有利的公司进行替代的初始企业合并,或以对股东不那么有利的条件进行清算,而不是清算,在这种情况下,内部人将损失其全部投资。因此,内部人士在确定GIO是否是与之进行业务合并的适当企业和/或在评估业务合并的条款方面可能存在利益冲突;以及 |
| ● | 预计在业务合并完成后,ACIC首席执行官、总裁兼董事长Joel Shulman博士将被选举为合并后公司的董事。因此,在未来,该董事将获得合并后的公司董事会决定支付给其董事的任何现金费用、股票期权或股票奖励。 |
除了ACIC的内部人士在企业合并中的利益外,ACIC的股东还应该意识到,Cantor可能拥有与ACIC股东的利益不同或不同的财务利益,包括Cantor及其指定人员拥有75万份私人认股权证,这些认股权证由Cantor以每份私人认股权证1.00美元的价格购买,如果企业合并不能完成,这些认股权证将一文不值。虽然私人认股权证的某些权利不同于公开认股权证持有人的权利,但Cantor或其指定人员持有的750,000份私人认股权证的总价值估计约为[·]美元,假设私人认股权证的每份认股权证价值与公开认股权证于2023年[·]日在OTCM上的收盘价[·]美元相同。
交易所上市
ACIC单位、普通股和认股权证分别在场外交易市场交易,交易代码分别为“APNCU”、“APNC”和“APNCW”。ACIC单位于2021年11月9日开始公开交易,普通股和认股权证分别于2021年12月30日开始公开交易。收盘后,ACIC单位、普通股和公开认股权证将不再交易。合并后的公司拟申请将其股票和认股权证在OTCM或全国性证券交易所上市,股票代码分别为“[·]”和“[·]”。普通股在OTCM或国家证券交易所上市是收盘的一个条件。无法保证合并后的公司在完成业务合并后能够满足初始上市要求或继续上市要求。
业务合并的背景
ACIC是一家空白支票公司,于2020年12月28日作为特拉华州公司成立,目的是与一项或多项业务进行合并、股本交换、资产收购、股票购买、重组或其他类似业务合并。
ACIC的首次公开发行
2021年11月12日,ACIC完成了17,250,000个单位的IPO,其中包括承销商以每单位10.00美元的价格全额行使2,250,000个单位的超额配股权,总收益为172,500,000美元。在完成首次公开发行的同时,ACIC完成了以每份私募认股权证1.00美元的价格向保荐人和Cantor出售820万份私募认股权证的交易,Cantor是ACIC首次公开发行的承销商代表,总收益为820万美元。在首次公开发行之后,包括充分行使超额分配选择权和私人配售,共有175950000美元(或每单位10.20美元)存入信托账户。
2022年特别会议
2022年12月21日,ACIC召开了2022年特别会议,ACIC的股东批准了修订ACIC当时存在的经修订和重述的公司注册证书,将ACIC必须在此之前完成企业合并的日期从2023年2月12日延长至2023年8月14日,或董事会确定的延长完成初始企业合并所需时间的较早日期。因此,ACIC可以再延长一个月,最多延长六次,直至2023年8月14日(每次“延长”)。就延期而言,15,747,797股ACIC普通股被赎回。因此,从信托账户中释放了大约1.621亿美元,用于支付这些赎回股东的款项。截至记录日期,有[·]股ACIC普通股已发行和流通。
为了促使公众股份留在ACIC,并就延期而言,对于股东未因2022年特别会议而赎回的ACIC普通股股份,ACIC将为未赎回的每股公众股份存入一笔金额为125,000美元或(y)0.05美元(以较低者为准)的金额(“每月金额”)。赞助商有
133
同意将每月金额从0.05美元增加到0.055美元,用于每一股未被赎回的公众股票,同时保留每月125,000美元的最高金额。如果ACIC不能在2023年8月14日之前完成其初始业务合并,它将根据现行章程被迫解散和清算。
目标搜索
在与GIO签订业务合并协议之前,ACIC除其他外,利用ACIC管理层和ACIC董事会成员的网络和业务关系,对潜在的业务合并交易进行了彻底的研究。与GIO拟议业务合并的条款是ACIC和GIO及其各自的代表和顾问进行彻底谈判的结果,如下文所述。
自首次公开发行之日起至《企业合并协议》签署之日止,ACIC管理层和ACIC董事会评估并考虑了一些潜在的目标公司,作为可能的企业合并交易的候选者。ACIC的代表与许多个人和实体进行了接触和接触,这些个人和实体主动提出向ACIC介绍各种行业和部门的潜在收购机会,最初侧重于美国和北美市场,后来侧重于全球机会。
在寻找潜在业务合并目标期间,ACIC保留了一份不断变化的高度优先潜在目标清单,该清单不时更新和补充,并由ACIC管理层定期与ACIC理事会共享。
在此期间,行政协调会及其代表:
| ● | 在金融服务、科技、汽车、医疗保健和消费品等广泛领域,确定并评估了160多个潜在的企业合并机会; |
| ● | 订立保密协议并参加电话会议和虚拟会议,以便进行初步尽职调查,并与24家潜在目标公司的代表进行讨论;以及 |
| ● | 向19家潜在目标公司提供了初步的非约束性意向书或意向书,并与GIO以外的5家潜在目标公司签订了非约束性意向书。 |
ACIC根据与ACIC董事会在评估与GIO的潜在业务合并时使用的标准相同或相似的标准(如下文所述)审查了潜在的收购机会,其中除其他标准外,包括潜在目标公司经营和计划经营的市场以及这些公司在这些市场中的定位、增长潜力、管理团队的领导力和经验,以及潜在目标公司似乎在多大程度上受益于通过业务合并交易成为美国上市公司。ACIC最终决定不进行任何其他潜在的收购机会,因为根据ACIC董事会和管理层的判断,其他潜在的业务合并目标没有达到ACIC的估值预期,或者没有提供像GIO那样有吸引力或可行的业务合并机会。
与GIO以外的候选人谈判过程的说明
首次公开发行完成后,ACIC的代表与一些财务顾问、咨询公司、投资银行家、风险资本家进行了广泛的讨论,并就潜在的收购机会与主要位于美国和发达市场的公司管理层进行了直接沟通。尽管ACIC最初的搜索重点是在金融科技、媒体、游戏和金融服务以及财富咨询和资产管理行业运营的目标,但在搜索过程中,ACIC观察到,这些行业的市场状况使它们不如其他领域的潜在目标有利,因此ACIC考虑的最终潜在收购机会(包括GIO)是在其他行业,如下文进一步描述的。
以下是ACIC考虑的除GIO之外的其他目标的摘要,以及ACIC没有继续考虑这些候选目标的原因。
| ● | 目标A:从2022年6月开始,ACIC管理层讨论了与面向消费者的技术公司Target A进行业务合并的可能性,最终导致ACIC和Target A于2022年7月21日签订了一份不具约束力的意向书。从2022年8月开始的大约八周期间,目标A的代表 |
134
| 和ACIC分别进行了多次讨论和谈判,目标A向ACIC提供了有关目标A的技术、知识产权、财务业绩和管理层对目标A增长潜力的看法的尽职调查信息。经过这些讨论,ACIC和目标A最终确定,目标A不太可能准备在ACIC要求的时限内推进企业合并交易,因此各方决定在第三个日历季度结束时终止讨论。 |
| ● | 目标B:2022年秋季中旬,ACIC管理层与高档自行车、电动自行车和服装公司Target B开始讨论进行业务合并交易的可能性,随后双方签订了一份不具约束力的意向书。从2022年10月开始,Target B通过一个虚拟数据室向ACIC提供尽职调查信息,ACIC管理层和Target B管理层就进行交易的可能性举行了多次电话会议,一直持续到2022年12月。然而,最终,ACIC和Target B出于对Target B及时提供PCAOB审计的财务报表的能力的担忧,决定终止这份不具约束力的意向书。 |
| ● | 目标C:Target C,一家总部位于英国的医疗器械公司,与ACIC管理层开始讨论在2022年秋冬季进行业务合并交易的可能性,双方于2022年11月底就此签订了一份不具约束力的意向书。此后,双方继续讨论进行业务合并的可能性,直到2022年12月最终决定结束这种讨论,因为目标C无法在ACIC要求的时限内提供经PCAOB审计的财务报表。 |
| ● | 目标D:2022年底,ACIC考虑与在线互动娱乐网络Target D进行业务合并,并与Target D签订了一份不具约束力的意向书。然而,此后不久,ACIC和Target D相互同意,由于时间安排和其他预期不一致,终止了此类讨论,并终止了先前执行的意向书。 |
| ● | 目标E:同样在2022年底,ACIC董事会的一名成员将ACIC介绍给总部位于美国的消费者包装食品和补充剂公司Target E,经过ACIC管理层和Target E管理层的初步讨论,双方于2022年12月签订了一份不具约束力的意向书。ACIC、Target E及其各自的代表和顾问在随后的几周里参加了多次电话会议和虚拟会议,包括管理层介绍和尽职调查会议。与Target E的经营历史、财务业绩以及Target E管理层的业务计划和增长说明书相关的尽职调查工作一直持续到2023年1月底,当时Target E通知ACIC,它希望停止讨论,以便专注于内部举措。 |
ACIC和GIO之间谈判的说明
2022年6月8日,GIO的财务顾问TAG Investment Bankers Ltd.(“TAG”)的Amal Sharma就ACIC与GIO之间的业务合并交易的可能性联系了舒尔曼博士。在Shulman博士与TAG的代表进行了初步讨论后,ACIC最初决定主要关注其他潜在业务合并机会,这些机会具有较早的潜在收入,但随后于2022年10月恢复了ACIC与TAG的代表之间的讨论,导致ACIC与GIO签订了保密协议。签署保密协议后,代表ACIC的Shulman博士与Srivastava博士和Patel先生以及TAG的代表举行了一系列电话会议,讨论进行企业合并交易的可能性。在这些会议上,斯里瓦斯塔瓦博士和帕特尔先生概述了斯里瓦斯塔瓦博士及其团队正在开展的以干细胞为基础的科学研究和开发活动,并向ACIC介绍了GIO打算如何利用他们的临床专业知识开发相关的专门知识,以解决全球血液短缺问题,并为投资者创造商业价值。
2022年10月11日,舒尔曼博士向GIO的代表提交了一份意向书初稿(随后修订,“意向书”),ACIC和GIO继续讨论这份意向书,直到双方在2022年10月14日最终执行了意向书。讨论的主题包括但不限于:(一)拟议的GIO投资前估值;(二)可向GIO股东发行的盈利股票的条款和结构。除其他条款外,意向书还包括:(一)相互排他期;(二)向GIO股东提议的交易对价,包括新发行的ACIC A类普通股股票,总价值为2.50亿美元(可根据GIO的期末债务(扣除现金)、营运资金、交易费用和交易奖金(如果有的话)进行调整),每股价格等于10.20美元;(三)GIO普通股重要股东的六个月收盘后锁定期。在2022年10月至2023年1月期间,斯里瓦斯塔瓦博士和帕特尔先生以及GIO的顾问
135
2023年1月下旬,ACIC管理层继续与GIO及其代表积极讨论在双方之间进行业务合并交易的可能性。2023年2月1日,ACIC和GIO签订了一项LOI修正案(“LOI修正案”),有45天的相互排他期。
2023年2月2日,GIO向ACIC及其法律顾问Ellenoff Grossman & Schole LLP(“EGS”)授予访问虚拟数据室(“VDR”)的权限,其中包含有关GIO的更详细信息,以便EGS开始对GIO进行法律尽职调查。
2023年2月8日,ACIC(包括EGS)和GIO(包括TAG和GIO的法律顾问Winston & Strawn LLP(“WS”))的代表通过视频会议举行了“启动”会议。在本次会议上,与会者讨论了意向书中概述的拟议业务合并的条款以及拟议业务合并交易的预期时间表和概览。
在2023年2月1日至业务合并协议签署之日(“签署日期”),ACIC的代表与GIO管理层举行了广泛的会议,收集了与ACIC对GIO和拟议业务合并的评估相关的信息。ACIC管理层在评估公司和金融市场方面拥有丰富经验,他们收集了信息并编写了财务分析报告,供ACIC董事会在评估拟议的业务合并时分享,下文“ACIC Management Financial Analyses”标题下进一步说明了这一点。
在执行《意向书》修正案和签署日期之间的这段时间里,ACIC的法律顾问EGS根据GIO在VDR中提供的文件和其他信息进行了法律尽职调查,并与GIO管理层和WS举行了会议。尽职调查的重点包括GIO的资本化和知识产权。为促进法律尽职调查工作,EGS编制并向WS发送了一份惯常的法律尽职调查请求清单,该请求得到了GIO及其律师的书面答复、会议期间的口头答复以及GIO在VDR中提供相应文件和其他信息的答复。在接下来的几个星期里,直至签署日期,ACIC、GIO及其各自的顾问继续举行补充尽职调查会议,并进行相关沟通;ACIC管理层定期向ACIC董事会提供最新情况,让董事会随时了解尽职调查和交易谈判的情况。
在这些努力的同时,舒尔曼博士、帕特尔先生和斯里瓦斯塔瓦博士继续举行电话会议和虚拟会议,讨论GIO对其业务线(统称为“业务线”,正如本登记/代理声明中题为“GIO公司概览”的部分进一步描述的那样)和拟议业务合并交易的其他要素,包括但不限于在交易中可向GIO股东发行的Earnout股票的数量、在交割之前和作为交割条件而签订的GIOSTAR供应协议的范围、Patel先生和Srivastava先生各自将签订的非竞争协议的条款和范围,以及GIO可能执行其业务战略要素的司法管辖区、时间表和顺序。在此期间,ACIC管理层继续开展业务尽职调查,包括与科学家和其他行业专家进行电话会议,这些专家熟悉斯里瓦斯塔瓦博士迄今为止的工作,涉及干细胞和GIO为实现其Universal RBC业务线而预计将开发的技术,包括于2023年2月28日与一位与斯里瓦斯塔瓦博士发表过科学论文的医生进行电话会议,以及于2023年2月16日与一家科学设备公司的高管进行电话会议,讨论为Universal RBC开发生物反应器的可能性。
137
在ACIC继续进行尽职调查的同时,双方及其法律顾问讨论并谈判了《企业合并协议》的条款,EGS于2023年2月12日编写并向WS发送了该协议的初稿。在2023年2月12日至2023年3月8日期间,ACIC、EGS、GIO和WS交换了几份业务合并协议草案。在此期间,EGS和WS举行了多次电话会议和虚拟会议,讨论业务合并协议的条款,包括在2023年2月15日、2023年2月20日、2023年2月24日和2023年3月7日举行的会议。ACIC和GIO的代表参加了许多此类电话会议和会议。在这些电话会议和虚拟会议期间讨论的议题包括但不限于:(一)在签署之日将成为企业合并当事方的GIO普通股东;(二)GIO普通股东的登记权;(三)是否将根据GIO交易费用和债务调整交易所对价;(四)拟议的GIOSTAR供应协议的条款;(五)GIO提交符合PCAOB标准的已审计财务报表的时间;(六)ACIC和GIO各自的陈述、保证和契约;(七)收益参与方,(viii)根据将在收盘时通过的激励计划预留发行的股份数量,但须经ACIC股东批准,(ix)收盘条件和(x)满足上市要求。在《企业合并协议》的谈判过程中,双方还交换了《企业合并协议》和《投票协议》、《锁定协议》、《非竞争协议》和《卖方登记权协议》等附属协议(“附属协议”)的草案,并就其条款进行了谈判。ACIC管理层定期向ACIC董事会通报与GIO谈判的情况。
此外,在进行上述工作的同时,ACIC与几家第三方公司举行了会议,讨论聘请这些公司作为ACIC的财务顾问,以便从财务角度评估拟议的业务合并对ACIC股东的公平性。在这些会议之后,在审查了潜在公平意见提供者各自的专业资格,并讨论了他们在从财务角度审查交易对ACIC股东的公平性时分析交易属性的能力和时间表之后,ACIC决定聘请EverEdge Global Ltd.(“EverEdge”或“公平意见提供者”)作为ACIC的公平意见提供者。EverEdge Global Ltd.是一家专门从事商业估值实践和一般无形资产的全球咨询和交易公司。
《企业合并协议》和《附属协议》的执行版本包含若干反映双方在2023年2月12日之后进行谈判的重要条款,其中包括:(一)将在交割前执行的《GIOSTAR供应协议》的重要条款;(二)将某些股东排除在收益之外;(三)用于确定在收益期间是否实现股价目标的VWAP期;(四)合并后公司董事会的组成;(五)取消对交换对价的某些调整。
138
ACIC管理层定期向ACIC董事会通报与GIO谈判的情况。2023年3月8日,ACIC董事会召开了一次虚拟会议,审议《企业合并协议》的条款以及由此设想的交易。ACIC的法律顾问向ACIC董事会简要介绍了以下情况:(一)《企业合并协议》的条款及其所设想的交易;(二)董事在考虑是否批准潜在的企业合并交易时的受托责任。也是在这次会议上,EverEdge审查了其关于GIO和业务合并的财务分析,并向ACIC董事会提出了口头意见,随后通过提供书面意见予以确认,从财务角度评价拟议的业务合并(包括根据业务合并协议可向GIO持有人发出的对价)对ACIC股东的公平性。Shulman博士还向ACIC董事会介绍了ACIC管理层对GIO潜在未来价值的财务分析,以及ACIC管理层认为拟议中的与GIO的业务合并可能代表的商业机会,该分析基于与ACIC董事会在会议之前共享的信息和材料。经过审查和讨论,包括ACIC董事会成员向法律顾问和ACIC管理层提出的问题,ACIC董事会除其他外一致(1)确定,《企业合并协议》的条款和由此设想的交易(包括根据协议向GIO普通股东发行交易所对价)对公司公平,并符合公司的最佳利益,ACIC及其股东;(2)批准并宣布《企业合并协议》及其所设想的交易是可取的;(3)指示将《企业合并协议》提交ACIC股东批准;(4)建议ACIC股东通过《企业合并协议》。
在签署日期2023年3月8日,ACIC和GIO签署了业务合并协议和适用的附属协议,并发布了一份联合新闻稿,宣布ACIC和GIO已就拟议交易签订了业务合并协议。自签署之日起,双方就完成业务合并的时间以及与此相关的各种筹备工作进行了定期讨论,并预计将继续进行讨论。2023年5月10日,ACIC和GIO对《企业合并协议》进行了修订,据此对《企业合并协议》进行了修订,修订内容如下:(i)修订“全国交易所”的定义,在某些情况下,ACIC的股票必须作为收盘的条件上市,以包括由OTC Markets Group Inc.运营的交易市场;(ii)对交易所对价的计算进行某些澄清更改,(iii)对GIO与协议中定义的“公司重组”有关的契约作出某些其他调整。
ACIC理事会的建议和业务合并的理由
行政协调会理事会在评价业务合并时,与行政协调会管理层及其顾问进行了协商。在达成一致决议(一)认为《企业合并协议》及其所设想的交易(包括根据协议发行ACIC股票作为交换对价)是可取的,并且符合ACIC的最佳利益,以及(二)建议ACIC股东通过《企业合并协议》时,ACIC董事会各自考虑了一系列因素,包括但不限于下文讨论的因素。鉴于在评估业务合并时考虑的因素众多且种类繁多,行政协调会认为,对其在作出决定和支持其决定时考虑的具体因素进行量化或以其他方式赋予相对权重是不可行的,也不会试图这样做。行政协调会理事会认为,其决定是基于现有的所有资料以及提交给它并由它审议的各种因素。此外,个别董事可能对不同的因素给予了不同的权重。本节对ACIC的业务合并原因及所有其他信息的解释具有前瞻性,因此,应结合“关于前瞻性陈述的注意事项”中讨论的因素来解读。
行政协调会理事会认为,与企业合并有关的若干因素总体上支持其订立《交易协议》的决定及其所设想的交易,其中包括但不限于以下重大因素:
| ● | 目标与行业机遇保持一致。明确的行业趋势和全球医疗需求似乎支持了GIO的既定目标,即发展通用红细胞、抗衰老诊所和活性化妆品业务。 |
| ● | 管理临床专业知识.阿南德·斯里瓦斯塔瓦博士在干细胞和GIO在科学界和医学界的人脉方面拥有丰富的临床经验,这可能使GIO处于有利地位,能够执行其既定的商业计划。 |
| ● | 多方面的业务战略.GIO管理层制定了开发干细胞衍生产品和服务并将其商业化的多方面计划,但时间表不同,视各种意外情况而定。利用干细胞进行多种 |
139
| 在不同的司法管辖区,GIO可能比一家追求单一产品、技术或服务的未实现收入的公司更有可能获得成功。 |
| ● | 公平意见.EverEdge向ACIC董事会表示,根据意见中提出的假设、条件、限制和其他事项,从财务角度来看,在拟议的业务合并中交付给GIO股东的对价对ACIC的证券持有人是公平的。 |
| ● | 有吸引力的潜在未来价值.如果GIO的商业计划成为现实,ACIC管理层对上市公司和上市交易的财务分析表明,相对于指导性交易和上市公司,GIO的潜在未来价值对投资者来说是一个有吸引力的机会,前提是GIO获得监管批准和其他条件,包括获得资本和其他资源。 |
| ● | 优惠交易条款.ACIC认为拟议的业务合并的条款是有利的,其中包括在达成某些基于交易价格的交易后,未来可能发行盈利股票,以及交易条款不包括最低现金结算条件,这降低了业务合并不会结束的风险。 |
行政协调会理事会还审议了与业务合并有关的各种不确定性和风险以及其他潜在负面因素,包括但不限于以下方面:
| ● | 商业计划可能无法实现.每个业务线都具有前瞻性,由于各种原因,GIO的业务计划可能无法全部或部分实现,这可能限制GIO创收或在近期或根本无法盈利的能力; |
| ● | 赎回风险.大量ACIC股东选择在业务合并完成之前赎回其股份的可能性,这将导致GIO获得的现金收益减少,并降低ACIC证券在拟议的业务合并完成后在国家证券交易所上市的可能性; |
| ● | 估值挑战.由于GIO没有当前的业务或财务历史,其前景以及GIO在执行其业务计划时可能面临的风险难以评估,ACIC董事会可能没有获得使其能够准确预测GIO未来潜在价值的所有必要信息; |
| ● | 竞争.GIO的商业计划取决于其在几个竞争激烈的市场销售产品和服务产生收入的能力,GIO将面临来自参与这些市场的公司的激烈竞争,其中许多公司比GIO更成熟、资本更充足、拥有更多资源,以及其他优势。此外,不能保证GIO或其关键科学家拥有知识产权、专门知识或商业秘密,或有能力利用上述任何一项来开发产品或服务,目前或将来达到监管机构批准或商业化的程度,这些产品或服务比竞争对手的产品或服务独特、优越或更有效,或者,如果GIO在干细胞相关开发工作中取得成功,GIO将比其竞争对手处于更有利的地位,能够以有利于投资者的方式或按照有利于投资者的时间表将任何产品、服务或技术推向市场; |
| ● | 资本要求.GIO启动和发展任何业务线都需要大量资本和其他资源,这些资源可能根本无法以有吸引力的条件提供给GIO; |
| ● | 计划中的举措可能无法实现.由于监管限制、资本要求或其他原因,GIO可能无法按照GIO管理层认为可能的方式或时间表开发其计划的业务线;如果开发,GIO可能提供的任何产品或服务可能不会被市场参与者或客户接受,或者可能不具有竞争力; |
| ● | 临床开发是一个漫长而昂贵的过程.开发通用红细胞和相关技术,使其为临床前和临床试验和试验做好准备,并成功获得FDA和其他适用的监管批准,可能是一个漫长而昂贵的过程,GIO将需要获得大量资金和其他资源来实现这些目标,而GIO可能无法以对GIO有吸引力的条件获得这些资源(如果有的话); |
140
| ● | 对使用人类干细胞的限制某些司法管辖区.在一些法域,对人类干细胞及其衍生产品的某些用途的限制可能会限制GIO认为对业务线重要的某些产品和服务的可行性,以及GIO追求和商业化的能力,这可能会使GIO更难创收或盈利; |
| ● | 股东投票.ACIC的股东可能无法提供实施业务合并所需的相应投票的风险; |
| ● | 关键人员和专门知识的损失.GIO首席科学官Srivastava博士主要负责GIO商业计划目前所依赖的部分或全部科学知识、商业秘密和知识产权,GIO首席执行官Patel先生主要负责GIO商业计划目前所依赖的部分或全部商业和运营知识、商业秘密和知识产权,如果Srivastava博士或Patel先生由于任何原因不再是GIO的一部分或减少参与GIO或以任何其他方式不能或不能提供GIO的全部利益,就Srivastava博士而言,他的科学专长或他在干细胞方面的工作成果,或就Patel先生而言,他的业务或业务专长目前或将来对GIO而言,GIO可能无法执行其业务计划或其实质性方面,GIO产生收入或执行业务线的前景将受到重大不利影响; |
| ● | 关联方交易和潜在利益冲突.Srivastava博士和Patel先生将与干细胞相关的商业秘密、技术诀窍和知识产权专属于GIOSTAR,GIOSTAR是由Srivastava博士和Patel先生控制并拥有多数股权的实体,GIO成功或完全依赖于这些商业秘密、技术诀窍和知识产权,而GIOSTAR又授予了独家许可(在有限的例外情况下),可将此类商业秘密、技术诀窍和知识产权用于GIO的四个业务线所涉及的活动。根据这种安排,GIOSTAR可将这些商业秘密、专门知识和知识产权用于业务线以外的目的,或继续在哥斯达黎加、墨西哥和印度这三个国家拥有和经营抗衰老诊所,在这些国家,GIO将不享有从事这一业务线的专属权利。此外,除非GIO能够为化妆品或其他产品制造AHSDM或其他“活性成分”,否则如果GIO开发Active Cosmetics业务线,GIO预计将依赖根据GIOSTAR供应协议交付给GIO的AHSDM来启动和制定此类业务计划。如果GIOSTAR出于任何原因不履行或遵守GIOSTAR许可协议和排他性协议的条款,或Srivastava博士或Patel先生未能使GIOSTAR完全满足上述任何安排的条款和要求,包括在GIOSTAR和GIO或Srivastava博士和Patel先生的商业利益与GIO的商业利益发生冲突时,GIO的业务和未来的招股说明书将受到重大不利影响。 |
| ● | 利益冲突.ACIC董事会可能受到ACIC最佳利益与董事个人利益之间冲突的影响,包括如果企业合并未能完成,而ACIC因无法在现行章程允许的时间范围内完成另一项企业合并而被迫清算的可能性,ACIC内部人士拥有的创始人股份和私人认股权证将一文不值; |
| ● | 上市资格风险s.在收盘时或收盘后,ACIC或合并后的公司可能也无法满足或保持其证券在美国国家证券交易所上市的资格或资格的风险; |
| ● | 监管风险和不确定性.相关地区适用的合规成本监管框架可能对GIO开发或执行业务线的能力产生不利影响的风险; |
| ● | 关闭条件.完成业务合并的条件是满足或放弃某些关闭条件; |
| ● | 诉讼.对企业合并提出质疑的诉讼的可能性,或给予永久禁令救济的不利判决可无限期地禁止企业合并的完成; |
| ● | 上市公司风险.为私营实体GIO准备适用的披露和上市要求所面临的挑战,GIO作为美国国家安全交易所的上市公司将受到这些要求的约束; |
| ● | 可能无法实现效益.可能无法充分实现或无法在预期时间范围内实现业务合并的潜在效益的风险; |
141
| ● | 获得GIO少数股权的ACIC股东.ACIC股东持有GIO少数股权的风险; |
| ● | 费用和开支.与完成业务合并有关的费用和开支可能超出预期;以及 |
| ● | 其他风险因素.与GIO及其计划的业务线有关的各种其他风险因素,如题为"风险因素”出现在这份联合代理声明/同意征求声明/招股说明书的其他部分。 |
在评估上述利益冲突时,ACIC董事会得出结论,潜在的不同利益将得到缓解,因为(i)这些利益已在ACIC首次公开发行的招股说明书中披露,并在本委托书/招股说明书中披露;(ii)在ACIC与任何其他目标企业或业务的业务合并中,这些不同利益中的大部分将存在;(iii)保荐人将持有合并后公司的股权,其价值将在交割后基于合并后公司股票的未来表现。此外,ACIC的独立董事在评估企业合并时审查并考虑了这些利益,并作为ACIC董事会成员一致批准了合并协议和相关协议以及由此设想的交易,包括企业合并。
以上关于行政协调会理事会审议的重要因素的讨论并非详尽无遗,而是阐述了行政协调会理事会审议的主要因素。
某些财务资料
关于ACIC对与GIO的潜在业务合并的评估,ACIC管理层进行了某些财务分析,如下文所述(统称为“ACIC管理层分析”),这些分析是ACIC董事会所依赖的主要财务信息(ACIC董事会根据其专业经验和资格认定ACIC管理层有资格在评估与GIO的潜在业务合并时分析GIO的前景和价值)。另外,在签署日期之前,GIO管理层以公平意见提供者的身份,编制并向ACIC和EverEdge提供了下文进一步描述的某些说明性预测(“GIO管理层预测”),ACIC董事会也收到了这些预测,但ACIC董事会决定在关于GIO的决策中不依赖这些预测,如下文进一步描述。任何与GIO或未来业务线有关的财务信息(“财务信息”)本质上都是说明性的,因为GIO尚未开始运营或开展可能与业务线相关的业务活动(如果有的话),而GIO可能无法开展其中任何一项业务活动。与GIO相关的“业务合并背景”一节中描述的所有财务信息都反映了GIO管理层的预期业务战略,其中包含了关于科学发展和许多其他事件和情况的大量假设,这些事件和情况尚未发生,也可能永远不会发生;没有任何财务信息反映了GIO或任何其他业务的历史结果;财务信息也不代表对GIO的实际预测,因为GIO尚未就任何业务线或任何其他业务开始运营。这些财务信息,包括ACIC管理分析和GIO管理预测,仅供内部使用,不是为了公开披露,也不是为了遵守美国证交会公布的有关预测的准则或美国注册会计师协会为编制和列报预期财务信息而制定的准则。财务信息不应被视为公共指导,请注意,在就企业合并作出决定时,不要依赖财务信息,因为财务信息可能与实际结果存在重大差异。所有财务信息,包括但不限于GIO管理层的预测,都应与仔细检查和审查与GIO及其预期业务线相关的各种风险和不确定性一并阅读,这些风险和不确定性包括本注册/代理声明中标题为“风险因素”、“GIO管理层对财务状况和运营结果的讨论和分析”和“关于前瞻性陈述的注意事项”的章节中所述的风险和不确定性,并且在所有方面都受以下标题“资格和限制;附加信息”下所述的限制和限定条件的约束。
ACIC Management财务分析
在审议拟议的与GIO的业务合并时,ACIC董事会收到了ACIC管理层编写的财务分析报告(“ACIC管理层分析报告”),详情如下。尽管许多公司保持详细的财务预测以衡量业务表现,但GIO尚未开始运营,这限制了GIO提供可靠的详细预测以预测GIO或任何业务线的未来财务表现的能力。因此,行政协调会理事会在评价拟议的业务合并时并不依赖GIO的管理预测。ACIC管理团队拥有丰富的经验和技能,能够评估各个领域的业务
142
行业和ACIC董事会确定这些技能和专业资格使他们有资格进行ACIC管理分析,ACIC管理层向ACIC董事会提交了这些分析,ACIC董事会在决定批准拟议的业务合并(包括根据业务合并的条款向卖方交付的对价)时将其视为一系列重要因素之一,如在标题“ACIC董事会的建议和业务合并的理由”下进一步描述的那样。
ACIC管理层用于ACIC管理层分析的主要分析方法是指导性交易方法分析(“GTM Analysis”)和指导性上市公司分析(“GPC Analysis”),下文将进一步介绍这两种方法。为了进行ACIC管理层的分析,ACIC管理层检查了一组交易和上市公司的信息,ACIC管理层认为这些交易和上市公司的属性与GIO管理层告诉ACIC的三个业务线(Universal RBC、Anti-Aging Clinics和Active Cosmetics)相似。进一步使用或开发干细胞来治疗与新冠疫情相关的症状不包括在此类分析中,因为GIO管理层表示,此类权利或技术不是其预期的主要近期重点。然而,没有与GIO、业务线或拟议的业务合并直接可比的指导性交易或指导性上市公司,其中包括,因为GIO的业务本质上是前瞻性的,并且因为GIO希望追求三个业务线,每个业务线都有不同的特征和风险/回报概况。尽管存在这些限制,但ACIC管理层利用GIO管理层提供的关于其业务线未来计划的信息,确定GTM分析和GPC分析中分别包括的准则交易和准则上市公司在进行分析时与GIO具有合理的可比性。鉴于上述因素,而且在所有情况下,都以下文“资格和一般限制;补充资料”项下所列资料为前提,行政协调会管理分析的结果应被视为纯粹是说明性的。ACIC管理分析的结果不是为了代表预测或预测,也不是基于历史信息或关于GIO的任何其他信息,也不是关于未来事件或情况的实际事实或预测。受众多意外事件和因素的影响。财务信息不反映实际结果,而是对可能的未来结果的预测。ACIC管理层、ACIC董事会成员及其各自的代表均未就GIO或合并后公司的最终业绩向任何人作出或作出任何陈述。
准则交易分析
在批准企业合并时,ACIC董事会审查了ACIC管理层的分析,包括GTM分析,这些分析是根据ACIC管理层对2019年1月1日(相关指导性交易完成日期,即“指导性交易日期”)或之后完成的“上市”交易(在本例中包括首次公开发行和所谓的“反向收购”)的公开数据(来自订阅数据库Pitchbook)的审查和分析编写的。在这些准则范围内,在确定交易是否适合纳入ACIC管理层进行的GTM分析时,考虑了以下因素:(一)部门;(二)通过准则交易日期产生的公司总收入;(三)截至准则交易日期的时间表(相对于当前日期和相对于公司成立日期)。
利用上述标准,ACIC管理层确定了ACIC出于比较目的认为相关的47项准则交易(“准则交易组”),但如下文所述,没有一项选定的交易具有与拟议的业务合并相同的特征,或涉及与任何业务线(或作为一个组的业务线)相同的业务。
根据ACIC管理层于2023年3月1日通过Pitchbook获取的信息,ACIC管理层用作纳入准则交易组标准的生命科学公司类别可归纳如下:
| ● | 生命科学、医疗保健及邻近产品和服务部门:咨询委员会的管理侧重于涉及下列一个或多个类别的公司的交易,咨询委员会认为,就典型的发展轨迹和时间表而言,这些交易最有可能包括业务线或与业务线有相似之处(通常需要在商业化活动之前对研究和开发工作进行大量前期投资):(一)生物技术(包括主要从事生物技术或与基因有关的研究、开发、制造和销售产品的公司,但不包括没有医疗保健相关应用的生物技术相关产品的制造商);(二)制药,(iii)诊所/门诊服务(包括与医疗及保健诊所有关的支援服务)及(iv)药物发现(包括药物发现、开发、生产及生产邻近的分析工具、仪器、消耗品及服务)及(v)其他产品或服务可被定性为 |
143
| “保健技术”(例如,包括与保健有关的支助服务和系统)生命科学、医疗保健及相邻产品和服务”). |
| ● | 上市交易:在属于医疗保健、生命科学及邻近产品和服务类别的交易中,ACIC管理层选定的交易导致一家以前私有的公司成为一家上市公司("上市交易”)的股票在美国国家交易所上市,即在指导性交易、首次公开发行和所谓的“反向收购”(通常涉及一家私营公司与一家在合并时没有经营业务的现有上市“壳”公司的合并)的情况下,ACIC管理层认为这些类型的交易与拟议的企业合并类似,随后,GIO(目前是一家根据英格兰和威尔士法律组建的有限公司)预计将成为一家在美国交易所上市的上市公司的全资子公司。 |
| ● | 准则交易日期:在医疗保健、生命科学及相邻产品和服务类别的上市交易中,ACIC管理层选择了2019年1月1日至今完成的交易("最近准则交易日期"),因为ACIC管理层认为,由于市场条件和其他与生命科学公司和一般上市交易相关的因素,这些交易与GTM分析的潜在相关性要高于前期完成的交易。 |
| ● | 收益前公开交易:在保健、生命科学和邻近产品和服务类别最近有准则交易日期的上市交易中,ACIC管理层选定的交易涉及从成立到相关准则交易日期产生的总收入不超过200万美元的公司(称为"收入前"的准则交易日期)。ACIC管理层把重点放在涉及Pre-Revenue公司的交易上,因为ACIC认为在Pre-Revenue阶段从事Go-Public Transactions的公司具有类似于GIO和业务组合的属性,因为GIO处于发展的早期阶段,尚未开始产生收入。 |
| ● | 成立于2012年后:在医疗保健、生命科学及邻近产品和服务类别的上市交易中,凡涉及截至有关上市交易日期尚未取得收入的公司,ACIC管理层选择了涉及成立于2012年1月1日之后的私营公司的交易("成立于2012年后”),因为根据评估公司和交易的专业经验,ACIC管理层认为,在成立十年内进行Go-Public Transactions的Pre-Revenue公司更有可能代表涉及医疗保健、生命科学和邻近产品和服务类别的公司的Pre-Revenue Go-Public Transactions,而不是涉及自成立以来(截至适用的准则交易日期)持续时间短于十年或长于十年的公司的同行业Pre-Revenue Go-Public Transactions。 |
根据上述标准列入准则交易组的公司包括DISC Medicine(NAS:IRON)和Vor Biopharma(NAS:VOR)等公司,关于这两家公司的进一步信息见下文“准则上市公司分析”。
准则上市公司分析
GPC准则公司
除了GTM分析,ACIC管理层还审查和分析了ACIC管理层认为具有类似于GIO或一个或多个业务线属性的公司的公开数据(来自付费搜索平台S & P Capital IQ),这些数据作为ACIC管理层分析的一部分提供给ACIC董事会。如上所述(在“GTM分析”标题下),没有与GIO未来预期业务直接可比的上市公司指引。尽管存在这些限制,ACIC管理层还是选择了一组200家指导性上市公司(“GPC指导性公司”,统称为“指导性公司集团”),以及另外五家参考上市公司(“参考指导性公司”,包括“参考指导性公司集团”),用于GPC分析,尽管没有一家被选中的公司具有与GIO或GIO计划的业务线相同的特征。
144
ACIC管理层利用CapIQ上市公司数据库(“数据库”,除非另有说明,截至2023年3月1日(“访问日期”))的平台和分析工具,协助ACIC识别GPC Guideline Companies,并获取有关这些公司的某些公开信息,如下文所述。截至访问日期,在数据库中有证券在美国或非美国国家证券交易所上市的公司(“上市公司”)的总数中,ACIC的分析重点是在以下全球行业分类标准分类范围内的上市公司(“GICS”,指的是标普道琼斯指数公司和MSCI开发的分类,截至访问日期):
| ● | 全球存在:在截至查阅日期的数据库所包括的公司总数中,ACIC管理层选择了一组65000家上市公司,其证券在全球各国家交易所上市,以便将在北美以外和北美境内有业务和业务重点的公司纳入GPC Analysis(以下简称“GPC Analysis”)。全球存在类别”). |
| ● | 一般保健:在全球存在类别的公司中,ACIC将搜索范围缩小到大约5035家属于GICS一般“医疗保健”分类的上市公司,该分类包括医疗保健设备和服务提供商以及制药和生物技术公司(“一般保健类别”). |
| ● | 特定医疗保健类别:ACIC的搜索范围进一步缩小到一般保健类别内的大约3200家公司,这些公司被归类为属于以下GICS子类别之一,ACIC认为这些公司与其中一个业务线具有属性或潜在相似之处:(一)保健服务;(二)生物技术;(三)医药产品;(四)非处方药;(五)医药化学品;(六)植物产品;(七)医药研发;(八)生命科学工具和服务特定医疗保健类别”). |
| ● | 收入在0到200万美元之间:在特定保健类别内的公司中,ACIC重点关注自成立以来毛收入总额在200万美元或以下的约1000家公司("0至200万美元的收入类别”),考虑到GIO所处的发展阶段,ACIC认为GIO与GIO最相关。 |
| ● | 美国交易所:在收入类别为0至200万美元的公司中,ACIC选择了在美国国家证券交易所上市的435家公司(“美国交易所上市类别”)与GPC分析相关,因为各方有意让ACIC的证券在与企业合并相关的美国国家证券交易所上市。 |
| ● | 成立于2012年后:在属于美国交易所上市类别的公司中,有200家公司被确定为在2012年期间或之后注册成立,或其公开申报文件反映了运营启动日期("2012年后成立类别”),ACIC认为这与GPC分析的目的相关,因为GIO成立于2022年。 |
根据上述标准纳入GPC Companies Group的公司包括:(i)DISC Medicine(NAS:IRON),一家临床阶段的生物技术公司,致力于治疗血液疾病的候选药物;(ii)VOR生物制药(NAS:VOR),一家临床阶段的公司,成立于2015年,正在为癌症患者开发工程造血干细胞(eHSC)疗法。
145
附加参考准则公司
除了ACIC管理层为GPC分析目的选择和使用的200家Guideline Public Companies之外,ACIC管理层还考虑了另外五家在化妆品和医疗诊所及邻近服务部门运营的成熟上市公司(“参考Guideline Public Companies”),作为GPC分析的补充参考点,因为GIO计划设立抗衰老诊所和活性化妆品业务线。虽然《参考准则》中没有一家上市公司与抗衰老诊所和活性化妆品业务线相同,而且《参考准则》中上市公司的业务比GIO的业务成熟得多(除其他属性外,包括《参考准则》中上市公司建立的业务关系、行业知识、品牌和市场声誉,以及获得的财务和其他资源大大超过GIO目前可获得的资源),但ACIC管理层确定,《参考准则》中上市公司的收入来源(包括化妆品和美容护理产品的销售,抗衰老产品和诊所服务)与GIO希望从其活性化妆品和抗衰老诊所业务线产生的收入流有足够的相似之处,因此有关参考指南的公开数据上市公司是为ACIC管理层的GPC分析提供参考的有用参考点。根据上述标准,列入参考准则公司集团作为GPC分析参考点的其他上市公司包括:(i)ELF Beauty(纽约证券交易所代码:ELF):一家总部位于加利福尼亚州奥克兰的全球性化妆品和护肤品公司;(ii)Ulta Beauty, Inc.(ULTA);(iii)欧莱雅(OR.PA);(iv)Inmode(NAS:INMD),一家总部位于以色列约克尼姆的微创美容产品制造商和设计商;(v)Surgery Partners(NAS:SGRY),一家位于美国的外科设施网络和手术附近服务提供商,如诊断成像、实验室、物理治疗、伤口护理、麻醉和其他服务。
ACIC Management财务分析结果
如上所述,ACIC管理层采用的GTM Analysis,根据适用的上市交易时GTM交易组所包括的47家公司的属性,得出了3.09亿美元至4.3亿美元的预估值区间,这一估值大大高于拟议的业务合并条款所暗示的GIO未来潜在业务的总价值。
ACIC管理层根据与参考准则上市公司有关的数据,对纳入准则上市公司集团的200家公司进行了GPC分析,根据GPC公司的市值中值和均值,得出估值区间为1.46亿美元至4.09亿美元,该估值区间的中间值高于拟议业务合并条款所暗示的GIO潜在未来业务的总价值。
GIO管理预测
正如上文和下文披露中描述ACIC为此目的聘请的财务顾问EverEdge向ACIC提供的公平意见的部分进一步描述的那样,GIO管理层于2023年2月1日编制了关于GIO未来潜在业务的某些有限的财务预测,这些预测随后提供给公平意见提供者(但如上所述,ACIC董事会在其关于拟议交易的决策过程中没有依赖这些预测)。下文对这些财务预测和其中所载的重大假设作了简要说明,并在“ACIC的资本投资公司财务顾问的意见”标题下的段落中作了参考。GIO管理层编制并由公平意见提供者使用的财务预测不是GIO在正常过程中保持的详细财务预测,也不是为了公开披露而编制的。此外,由于GIO尚未开展业务,这些预测纯粹是说明性的,并非基于GIO的历史业务结果或财务报表,它们完全取决于对一项业务和业务范围的假设,这些假设对可能发生或可能不会发生的各种事件和情况尚不存在,并且在所有这些假设方面都受制于实际结果以及已知和未知的风险和意外事件,在许多情况下,这些风险和意外事件不在GIO和ACIC的控制范围内,而这是无法预先预测的。前瞻性信息,包括有关未来业务计划的信息,在本质上受到重大不确定性和意外事件的影响,在GIO的预测中,管理层的预测与实际的历史或当前事实无关,而是完全基于对尚未开始的业务活动的描述。前瞻性陈述也容易受到多种解释的影响,本质上反映了对一般商业、经济、监管、市场和金融状况以及其他未来事件的假设,所有这些都很难预测,其中许多超出了GIO和ACIC的控制范围。我们鼓励投资者仔细阅读本委托书/招股说明书中的信息,包括GIO的财务信息以及有关GIO业务的各种风险和不确定性的描述
146
本文在“风险因素”、“GIO管理层对财务状况和经营成果的讨论与分析”和“关于前瞻性陈述的注意事项”等标题下进行了描述。
由GIO管理层编制并与公平意见提供者分享的财务预测包括对业务线未来潜在收入和收益的有限估计,假设其中所载假设中包含的许多事件和情况发生在此类预测所反映的期间(包括但不限于GIO发展业务线的努力按照GIO管理层在编制GIO管理层预测时的预期进行。GIO管理层的预测包括(i)2023年7月1日至2025年12月31日期间的收入和EBITDA预测(“2025年预测”,涵盖“2025年预测期”),GIO管理层认为这是其计划中的抗衰老诊所和活性化妆品业务线的合理预测期,特别是,假设在所有情况下,GIO管理层预测中包含的所有假设都是准确的,以及(ii)独立的说明性“扩展预测”,其中包含GIO管理层对计划业务线未来潜在的无杠杆税后自由现金流的预期(同样,在每种情况下,假设此类扩展预测中包含的所有假设都是准确的),2027年(“延长预测期”),即延长预测期GIO管理层根据其专业判断和行业经验,根据此类预测中包含的假设,认为是合理的。如下文所述,公平意见提供者EverEdge在其说明性估值分析中使用了有限的GIO管理层预测,并在下文“ACIC财务顾问的意见”标题下进一步说明了这一点。GIO管理层的预测并非基于GIO的历史财务或其他信息,该公司尚未开始运营。GIO管理层的预测既不是为公众使用或披露而编制的,GIO管理层的预测也不是为了代表对GIO实际或可能的未来结果的预测或估计。相反,在2023年2月1日,GIO管理层的预测是作为GIO管理层希望GIO追求的三个独立业务部门的潜在未来价值的说明性估计而编制的,考虑到没有一个业务线实际上已经开始或建立,而且GIO的计划可能会与GIO管理层在编制GIO管理层预测时的计划发生重大变化。
GIO管理层的预测本质上是说明性的,除其中包含的许多其他假设外,假设在预测期之前,GIO已经建立了其计划中的每一个业务线,并成功获得了所有必要的监管批准,不存在导致GIO改变其计划业务活动的重大延误、偏差或挑战,而这些活动是GIO管理层根据这些假设制定并纳入预测的。根据GIO管理层的专业判断和经验,GIO管理层认为,在编制此类预测时,纳入GIO管理层预测的假设是合理的;但前提是GIO管理层没有将干细胞相关产品商业化的直接经验,也没有将GIO科学家与干细胞相关的研发工作“货币化”的直接经验,实际结果可能与假设中包含的信息存在巨大差异,而且GIO的部分或全部计划业务活动和预期发展可能不会以GIO管理层预期的方式实现,或者根本不会实现。这些预测还假设,GIO的业务发展不受以下任何一项的限制:获得干细胞和其他原材料,或实验室、测试和试验要求,训练有素的技术人员;寻找研究、开发、试验、测试或FDA及其他监管和营销流程所需的资金;科学设备(包括从未开发过的生物反应器);来自其他公司或其他科学家或研究组织的竞争,这些公司也在开发基于干细胞的产品和服务;实现知识产权保护或保护的挑战;法律挑战或合规风险或任何其他风险,包括宏观经济、地缘政治、公共卫生等因素。GIO管理层编制并提供给EverEdge的预测包含了以下重要假设:
| ● | 抗衰老业务线.GIO与第三方在美国以外不同地区拥有和运营的抗衰老诊所网络有50/50的收入分成安排,这些诊所向客户提供基于GIO干细胞的治疗,每次治疗的费用为15000美元,因此GIO每次治疗的利润为3000美元(假设GIO的管理费用很少,在这种模式下,GIO不拥有或运营这些诊所),在预测期内,提供GIO治疗的诊所数量每年以4至16家新诊所的速度增长,在此期间,所有诊所每月总共提供8到24次治疗。根据这些假设,ACIC管理层的预测显示,在2025年预测的最后一个日历年,GIO的估计年收入和利润分别为690万美元和520万美元,在延长的预测期最后一年,估计年收入分别为3190万美元和2760万美元,假设在2025年预测的最后一个日历年和延长的预测期,GIO与该业务项目相关的费用分别不超过160万美元和430万美元; |
147
| ● | 活性化妆品业务线.GIO在GIOSTAR供应协议期限内(在延长预测期的最后一年之前,开发了内部生产AHSDM的能力)从GIOSTAR收到价值1350万美元的AHSDM,GIO以高于成本2倍的价格出售,在2025年预测期的最后一年和延长预测期的最后一年分别为GIO带来400万美元和1200万美元的估计年收入,在2025年预测期的最后一年和延长预测期的最后一年分别产生303万美元和1070万美元的利润,假设GIO的间接费用很少或根本没有(除已纳入SG & A估计费用的情况外,如下文所述);以及 |
| ● | 通用RBC业务线.GIO从外部获得1000万美元,用于资助通用红细胞的研究和开发,包括临床和临床前测试和试验以及FDA和其他适用的监管审批程序(包括估计770万美元,用于建造或购置51个生物反应器和相关活动的估计费用(第一个生物反应器的费用为20万美元,随后每个生物反应器的费用为15万美元),这使得GIO有能力从2025年预测期最后一年开始,每月生产133个通用红细胞,在剩余的预测期内,GIO以每台通用RBC设备120美元的价格出售,在2025年预测期的最后一年为GIO带来500万美元的估计收入,在延长预测期的最后一年带来6640万美元的估计收入,从而使GIO在2025年预测期的最后一年获得203万美元的估计利润,在延长预测期的最后一年获得3245万美元的估计利润。 |
| ● | 关于商品成本、费用和收益的假设 |
GIO管理层的说明性预测纳入了与预测期内业务项目的货物成本、费用和收益有关的以下假设:
| ● | 估计销售,一般和行政("SG & A")在2025年预测期的最后一个日历年,包括营销、研发、网络和业务发展费用在内的费用为507万美元,在延长预测期的最后一年为1440万美元; |
| ● | GIO不会因计划中的抗衰老诊所和活性化妆品业务线而产生任何成本,因为这些说明性预测(GIO管理层为预测目的所作的假设)不会拥有或经营提供GIO治疗的诊所,而且GIO的收入和利润来自GIOSTAR根据GIOSTAR供应协议向其提供的AHSDM的销售,并且在预测期结束之前,GIO已发展出内部能力,以客户预购或类似安排支付的成本生产可销售的AHSDM。 |
| ● | GIO建造或获得如此数量的生物反应器(根据GIO管理层的预测,假定总共有51个生物反应器)、实验室和其他设备、雇用操作生物反应器所需的科学人员和其他支助人员以及使GIO能够生产为GIO带来估计收入和收益所需的通用红细胞所需的其他费用,第一个生物反应器的估计费用为200000美元,另外50个生物反应器的估计费用为150000美元(共计770万美元),假定为此目的需要,并且GIO的所有这些成本都已资本化(因此在GIO管理层的预测中不作为预测期内收益的减少反映)。 |
| ● | 生物反应器的估计使用寿命为五年,从而产生假定的折旧和摊销("D & A”)在2025年预测期的最后一年收费279万美元,在扩展预测的最后一年收费869万美元,D & A根据行业知识和对科学和实验室设备成本的普遍熟悉程度,改变了GIO管理层的估计。 |
GIO管理层对业务线的预测所包含的假设所依据的信息本质上是不完整的,因为GIO尚未开始任何业务线的运营,而且作为一个组织,尚未将任何产品商业化或销售任何治疗或服务。尽管存在这些限制,但GIO管理层认为,根据管理层的观察、临床专业知识和行业知识,纳入其盈利预测所依据的假设的与商品、费用、研发成本和研发成本相关的估计是合理的,同时考虑到GIO计划的所有业务活动(如说明性预测中所反映的)都是推测性的,GIO的计划以及GIO在开始运营时可能面临的风险(已知和未知)可能导致GIO必须产生的成本和费用不同,可能与纳入假设的估计存在很大差异。业务线的某些要素可能比预测所依据的假设所反映的成本高得多。相对于通用RBC
148
例如,到目前为止,GIO并不知道有任何生物反应器已经建成,与生物反应器的设计、建造、维护和运营相关的成本可能超出GIO管理层目前的预期,可能需要大量资金。进一步的临床和临床前测试和试验以及监管申请和批准过程可能是昂贵、耗时和冗长的过程,而且在许多情况下,出现的挑战、成本和延误是申请人或其他过程参与者在此类努力和过程开始时无法预见的。如果没有在计划中的部分或全部业务线方面的经验、与上述业务相关的性质、范围和潜在费用,以及作为GIO计划举措一部分的许多其他业务活动和要素,就很难准确预测当前或可能成为GIO在执行其目前的业务线计划时可能产生的成本和费用,即使不是天生不可能。此外,随着GIO特有的基本事实和情况(更笼统地说)发生变化,GIO关于拟议业务线的计划可能(而且可以预期)会在预测期的时间线上发生变化,可能会发生重大变化。
ACIC’s Financial Advisor的意见
如上所述,在谈判业务合并和评估GIO的过程中,ACIC还会见了潜在的公平意见顾问,并决定聘请EverEdge担任其财务顾问,以便从财务角度评估拟议的业务合并(包括根据业务合并协议可向GIO持有人发出的对价)对ACIC股东的公平性。
EverEdge日期为2023年3月8日的书面意见全文载于本登记/代理声明附件E,其中除其他事项外,阐述了所遵循的程序、作出的假设、所考虑的事项以及对提出其意见的审查范围的限制和限制。EverEdge的意见最初以口头方式提交给ACIC董事会,随后于2023年3月8日提交了书面意见。该意见是针对ACIC董事会对拟议业务合并的评估提交给ACIC董事会的,并提供给ACIC董事会,供其参考和使用。该意见并不构成就拟议的企业合并向ACIC的有关官员或任何其他人提出的建议,包括ACIC的任何股东应如何就拟议的企业合并交易投票或采取行动的建议。EverEdge的意见不涉及拟议业务合并与ACIC可能采用的其他业务或财务战略相比的相对优点,也不涉及ACIC与GIO进行拟议业务合并交易的基本业务决定。在提出其意见时,EverEdge除其他外审查了:
| ● | 业务合并协议中规定的拟议业务合并的财务条款和条件; |
| ● | GIO管理层提供的预测; |
| ● | GIO管理层建议的某些准则上市公司和先例交易,因为它们具有与GIO预期追求的业务线的某些方面相似的属性; |
| ● | 其他可公开获得的行业信息(即各种股票分析师报告、宏观经济报告和关于指导公司的公开信息)、从虚拟数据室获得的信息以及从FactSet等数据库获得的相关市场数据; |
| ● | 与GIO管理层就GIO计划的业务线以及与GIO业务计划相关的关键假设和风险进行了确认性讨论,包括某些行业EV/EBITDA倍数、贴现率和营运资本假设(根据GIO管理层向EverEdge描述的GIO业务计划,EverEdge根据独立的行业研究对这些假设进行了比较,并认为这些假设是合理的);以及 |
| ● | 与GIO管理层就适当的单位经济和与GIO计划的业务线相关的关键指标进行了确认性讨论。 |
就其分析和意见而言,EverEdge假定并依赖公开获得的财务信息和其他信息的准确性和完整性,以及向EverEdge提供或以其他方式提供、与EverEdge讨论或由EverEdge审查的所有信息,而不对此类信息进行任何独立核实(并且不对此类信息的任何独立核实承担任何责任或义务),并进一步依赖ACIC管理层的保证,即他们不知道任何会使此类信息不准确或具有误导性的事实或情况,考虑到GIO管理层预测的说明性,以及GIO尚未就其拟议的业务线开始运营的事实。关于GIO管理预测,EverEdge假定,这些预测是根据反映当前最佳情况的基础合理编制的
149
GIO管理层对GIO未来潜在财务业绩的现有估计和诚信判断,假设其中包含的假设成为现实。EverEdge没有对GIO管理层的预测或预测所依据的假设发表任何看法。
就其分析和意见而言,EverEdge假定,在对其分析具有重要意义的所有方面,《企业合并协议》所载每一方的陈述和保证是真实和正确的,每一方将在交易结束前履行其根据《企业合并协议》必须履行的所有契约和协议,并且完成拟议交易的所有条件将得到满足,而无需放弃或修改。EverEdge还假定,在对其分析具有重要意义的所有方面,完成拟议交易所需的所有政府、监管或其他方面的同意、批准或放行将不受任何延迟、限制、限制或条件的限制。
就其意见而言,EverEdge没有对与GIO有关的财产或设施或GIO预期开展的可能的业务线或与之有关的业务活动进行任何实物检查。EverEdge没有根据任何与破产、无力偿债或类似事项有关的州或联邦法律评估GIO的偿付能力或公允价值。EverEdge的意见必然基于EverEdge截至2023年3月8日提供的信息,以及截至该日期存在和可以评估的金融、经济、市场和其他条件。后续发展可能会影响EverEdge的意见,EverEdge没有义务更新、修改或重申其意见。
EverEdge没有被要求就拟议的企业合并(包括就企业合并向GIO普通股股东交付的交换对价)从财务角度对ACIC股东的公平性以外的任何事项进行转递,也没有就该事项发表任何意见。EverEdge没有就拟议的企业合并对债权人或GIO其他群体的公平性发表任何意见,也没有就将向GIO的任何高级职员、董事或雇员或任何类别的此类人员支付或应付的任何补偿的数额或性质的公平性发表任何意见,无论是相对于拟议的企业合并交易还是其他方面。EverEdge没有被要求,也没有就《企业合并协议》或《交易所对价》的任何其他条款或方面,包括但不限于拟议交易的结构或形式,或《企业合并协议》所设想的任何其他协议或文书的任何条款或方面,或作为此种协议标的的交易,表达任何意见,其意见也没有涉及这些条款或方面。
EverEdge的意见没有涉及拟议的业务合并交易与ACIC可能采用的其他业务或财务战略相比的相对优点,也没有涉及ACIC参与拟议的业务合并交易的基本业务决定。信贷、金融和股票市场一直在经历不寻常的波动,EverEdge没有就这种波动对各方或拟议的业务合并的任何潜在影响发表任何意见或看法。
以下是EverEdge就EverEdge于2023年3月8日提交给ACIC董事会的与EverEdge提出的意见有关的重大财务分析摘要。然而,下面的摘要并不是对EverEdge所做分析的完整描述。所描述的分析的顺序和这些分析的结果并不代表EverEdge给予这些分析的相对重要性或权重。除另有说明外,以下定量信息以市场数据为基础,以2023年3月8日或之前存在的市场数据为基础,不一定代表当前市场状况。
EverEdge对GIO的财务分析摘要
市场方法–指引公开交易公司(GPTC)
EverEdge用作公平性意见评估基础的主要方法是市场法—— GPTC,如下文所述。
GPTC方法是一种用于对企业进行估值的市场指标,其依据是来自上市公司的交易倍数,这些交易倍数与GIO管理层向公平意见提供者表示GIO打算追求的预期业务线类似。EverEdge审查并比较了GIO管理层提供的某些说明性预测与以下选定的医疗保健行业部分上市同行的相应交易倍数和财务比率
150
例如长寿诊所、专注于红血球的生命科学和活性化妆品(在本节中称为“FO指南公司”):
FO指引公司(长寿诊所):
|
●
Bausch Health Companies Inc.
●
Artivion, Inc.
●
泰尼特保健公司
●
Cutera, Inc.
●
艾伯维公司。
|
●
波士顿科学国际有限公司
●
HCA健康护理公司
●
InMode Ltd.
●
Surgery Partners公司
|
FO Guideline Companies(Red Blood Cells focused Lifesciences):
|
●
LivaNova公司
●
雅培
●
ICU医疗公司。
●
Merit Medical Systems, Inc.
●
爱德华兹生命科学公司
|
●
美敦力公司
●
卡地纳健康集团
●
Haemonetics Corporation
●
Conmed Corporation
|
FO指引公司(活性化妆品):
|
●
雅诗兰黛公司。
●
Revlon, Inc.
●
Coty Inc.
|
●
金佰利公司。
●
e.l.f.美容公司。
●
欧莱雅。
|
尽管上面列出的FO指南公司中没有一家与GIO(或GIO计划的业务线)具有直接可比性,但EverEdge选择这些公司是基于其专业判断,因为这些公司的运营行业具有相似的业务特征,为了进行分析,EverEdge认为这些行业与GIO管理层表示GIO希望开展的计划业务活动(通用红细胞、抗衰老诊所和活性化妆品)的业务特征密切相关。
对于上述每一家FO指导公司,EverEdge选择了企业价值与EBITDA(EV/EBITDA)的倍数作为可比估值指标,以确定GIO潜在未来业务的隐含企业价值,这反映在FO指导公司最近提交的公开文件中,以及从FactSet提供的公开股票研究分析师预测中获得的共识估计,截至估值之日。GIO未来业务的隐含企业价值,假设GIO管理层预测中所包含的假设所依据的事件和情况发生,如提供给EverEdge,并在此方法下适用,是根据GIO管理层对所有三个潜在业务线的2025年预测(如上文所定义)的现值在综合基础上计算得出的(GIO管理层表示,假设GIO管理层预测中所包含的假设所依据的事件和情况发生,这将是一个合理的时间表,可以说明GIO业务计划的未来潜力)。
收入法-折现现金流量分析
作为对上述主要市场方法(GPTC)分析的确认补充,EverEdge还审查和分析了贴现现金流分析,以计算GIO的隐含企业价值,利用GIO管理层扩展预测(如上文所定义)中的说明性独立、无杠杆、税后自由现金流的估计,这些估计基于对GIO管理层表示GIO计划追求的每一个业务线的各种假设。
151
就其贴现现金流分析而言,无杠杆自由现金流定义为税后净收入,加上折旧和摊销费用,加上税后利息支出,减去资本支出,减去营运资本投资,加上/(减去)其他非现金支出/(收益)。
EverEdge在持续经营的前提下,对处于稳定增长状态的企业,使用戈登增长方法计算了GIO未来潜在业务的说明性终值。戈登增长方法被应用于对GIO管理层扩展预测中所反映的无杠杆自由现金流的估计。
为了补充收益法分析的目的,EverEdge对GIO扩展预测中包含的GIO五年预测期内的说明性无杠杆自由现金流量以及使用上述方法的终值进行了折现,以得出GIO的说明性企业价值估计值,假设GIO管理层预测中反映的关于GIO及其预期业务线的所有事实、情况和假设均按照GIO管理层预测中所述的在估值之日使用19.9%的时间加权折现率实现。贴现率是基于EverEdge对GIO未来潜在业务的特殊风险状况的判断,并结合行业和经济指标得出的。
杂项
上述某些财务分析的摘要并不是对EverEdge所提供的分析或数据的完整描述。在评估拟议的业务合并交易时,EverEdge进行了各种财务和比较分析,以便发表意见。编制公正意见是一个复杂的过程,不一定容易受到部分分析或简要说明的影响。选择上述分析或摘要的部分内容,而不将分析作为一个整体来考虑,可能会造成对EverEdge观点所依据的过程的不完整视图。EverEdge在作出其公正性决定时,考虑了所有分析的结果,并没有孤立地从其为发表意见而考虑的任何一项分析或因素中得出结论或就其所考虑的任何一项分析或因素得出结论。而EverEdge则是在考虑了所有分析结果后,根据自己的经验和专业判断,对公平性做出了判断。此外,EverEdge可能赋予某些分析和因素比其他分析和因素更多或更少的权重,并且可能认为某些假设比其他假设更多或更少的可能性。因此,上述任何特定分析或分析组合所产生的估值范围不应被视为EverEdge对GIO潜在未来价值的实际价值的看法。此外,EverEdge的分析涉及有关财务和经营特征的复杂考虑和判断,以及可能影响所用公司的收购、公开交易或其他价值的其他因素,包括对行业表现、一般商业、经济、市场和财务状况以及其他事项的判断和假设,其中许多超出了ACIC、GIO或其各自的管理人员、经理和顾问的控制范围。
EverEdge编写这些分析的目的是向ACIC董事会提供意见,说明从财务角度来看,交易所对价对ACIC股东的公平性。这些分析并不声称是评估,也不一定反映企业或证券实际可能出售的价格。这些分析中所载的结果、信息和估计数无意、也不应被解释或解释为表明未来的实际结果,而这些结果可能比这些估计数所建议的结果更有利或更不利。此外,EverEdge的分析完全依赖于GIO提供给EverEdge的信息,包括GIO管理层的预测,而没有经过EverEdge或ACIC的独立验证。EverEdge的分析中使用的估计、预测、说明性信息、商业计划、前景和其他信息,以及由此得出的结果,在本质上都具有很大的不确定性,如果未来的结果与这些估计中预测的结果存在重大差异,EverEdge不承担任何责任。
EverEdge公平意见的发布得到了EverEdge的一个意见委员会的批准。
根据EverEdge与ACIC签订的合同条款,EverEdge有权收取一笔与工作范围相适应的费用。ACIC还同意向EverEdge偿还任何合理且有文件证明的自付费用(包括任何差旅或搜索费用),并赔偿EverEdge因其业务而产生的某些责任。
ACIC聘请EverEdge提供基于EverEdge资质、经验和声誉的公平意见。EverEdge是一家专注于无形资产的全球咨询和交易公司,经常从事商业估值实践。
152
资格和限制;补充资料
提交给ACIC董事会并由其所依赖的ACIC管理层分析,以及GIO管理层编制并提供给公平意见提供者的预测,都不是有意的,也不应被解释为对GIO或合并后公司可能或实际的未来经营结果或财务业绩的任何类型的预测、估计、保证、指示或陈述。也不能保证ACIC在评估GIO时考虑了影响或可能在未来影响GIO业务的所有重大事实、情况和意外事件,其中许多是无法预测的。在考虑了ACIC管理层的分析、EverEdge向ACIC提交的公平性意见(本文进一步描述的每一项意见)以及本委托书/招股说明书其他地方描述的其他原因和因素后,ACIC董事会在其商业判断中得出结论,向ACIC股东推荐拟议的业务合并。然而,ACIC董事会在评估GIO时可能依据的信息不完整,不能准确反映GIO、其业务或合并后公司作为上市公司成功的可能性。由于这些原因以及其他许多原因,ACIC董事会可能没有对GIO进行正确估值,或者没有得出理性投资者可能不同意的结论。我们鼓励投资者仔细阅读本代理声明/招股说明书中包含的信息,包括GIO的财务信息以及本文中描述的有关GIO业务的各种风险和不确定性的描述,包括在“风险因素”、“GIO管理层对财务状况和经营成果的讨论和分析”和“关于前瞻性陈述的注意事项”标题下。
在本委托说明书/招股说明书中列入财务信息不应被视为表明ACIC、GIO、其各自的董事、管理人员、顾问或其他代表考虑或现在考虑此类财务信息以预测未来的实际结果,或支持或不支持您对业务合并提案投赞成票或反对票的决定。没有人就本财务信息中包含的信息,包括GIO管理层编制的预测信息,向ACIC的任何股东作出或作出任何陈述或保证。GIO将不会在其根据《交易法》提交的未来定期报告中引用财务信息,包括GIO管理层的预测。财务资料未经审计。GIO或ACIC的独立注册会计师事务所或任何其他独立会计师均未就本联合代理声明/同意征求声明/招股说明书所载或描述的财务信息编制、审查或履行任何程序,也未就此类信息或其可实现性发表任何意见或任何其他形式的保证,ACIC和GIO的注册独立会计师事务所对这些财务信息不承担任何责任。
上述说明性的GIO管理预测是由GIO的管理团队本着诚意制定的,考虑到有关预期业务活动的重大估计和假设假设,以及GIO目前对三个业务线的计划,这些假设是根据GIO管理层的专业经验和行业知识制定的,如上所述。这些假设不胜枚举,且具有高度的推测性,因为业务线尚未建立或开发,因此GIO的计划受制于GIO目前的计划,而且很可能会发生变化。这些假设包括,除其他事件和情况外,在假设的预测期内会发生下列情况:
| ● | GIO获得了50/50的收入分成安排(向GIO支付的相关间接费用有限),在美国以外建立了一个抗衰老诊所网络,提供GIO基于干细胞的治疗,假定每次治疗的价格为1.5万美元。在预测期内,全球诊所网络每年扩大4至16家新诊所,每家诊所每月向8至24名客户提供GIO的治疗; |
| ● | GIOSTAR根据GIOSTAR供应协议从GIOSTAR收到的AHSDM不会给GIO带来额外成本,由GIO作为独立产品或作为可纳入其他公司产品的“活性”成分出售,直接成本为2倍; |
153
| ● | GIO获得1000万美元的外部资本(未记录相关成本),用于建造或购买51个生物反应器(并为此雇用技术人员和实验室支持),总成本为770万美元,并获得FDA和所有其他必要的监管和营销批准(根据必要的测试、试验和安全协议),以便在2025年预测期最后一个日历年的1月之前开始销售通用RBC; |
| ● | 到2025年预测期最后一个日历年的1月初,GIO生物反应器每月生产133台Universal RBC,在预测期的剩余时间内,GIO以每台Universal RBC 120美元的价格出售,在延长的预测期的最后一年,GIO的年化收入和利润分别为6640万美元和3250万美元; |
| ● | 在整个预测期内(并在适用的情况下,在开始任何相关活动之前),GIO满足其在预测期内开展业务线活动的所有法域的所有适用监管要求(如相关,包括临床前测试、临床试验、营销和其他批准);以及 |
| ● | GIO在预测期内的成本和支出不超过GIO管理层预测中所反映的估计数,而且GIO可以获得资金为其活动提供资金,而无需支付GIO应承担的费用;以及 |
| ● | GIO能够在没有重大竞争、在开发拟议的业务线时面临的重大障碍(包括在建造生物反应器原型或确定抗衰老诊所或活性化妆品业务线的第三方合作伙伴方面的潜在延误)、监管障碍或其他可能导致风险、延误、成本和其他已知或未知挑战的不利影响或事件的情况下,成功地开展上述计划的业务线,其中许多挑战可能无法预见或在GIO的控制范围内。 |
财务信息,包括但不限于GIO管理层的预测,在许多方面都是主观的,特别是在业务线尚未开始的情况下。因此,不能保证财务资料将得到落实,或实际结果不会与财务资料中所反映的说明性结果有很大不同。由于GIO管理层的预测涵盖多年,这些信息就其性质而言,每年的预测性都会降低。GIO没有向任何人,包括ACIC保证财务信息的准确性、可靠性、适当性或完整性。GIO管理层及其代表均未就GIO与财务信息(包括但不限于GIO管理层预测)相关的最终表现向任何人作出或作出任何陈述。财务信息,包括但不限于GIO管理层的预测,既不是事实,也不是未来实际业绩的保证。由于GIO无法控制或预测的因素,GIO未来的财务结果可能与财务信息中的结果存在重大差异。
对80%测试的满意程度
根据纽约证交所上市规则,ACIC收购的任何企业,在执行初始企业合并的最终协议时,其公允市场价值至少相当于信托账户资金余额的80%(不包括信托账户持有的递延承销折扣,以及信托账户赚取的收入应缴纳的税款)。由于ACIC目前没有在纽约证券交易所或任何其他全国性证券交易所上市的证券,满足这一要求不适用于ACIC或企业合并,然而,尽管ACIC董事会决定与GIO进行拟议的企业合并交易之日,ACIC董事会仍考虑了纽约证券交易所的上市规则,尽管其证券已在OTC Pink Sheets上报价。在考虑了本注册/代理声明中题为“ACIC董事会的建议和批准企业合并的理由”一节中确定和讨论的因素后,包括ACIC管理层进行的财务分析,以及ACIC为此目的聘请的独立财务顾问EverEdge向ACIC提供的公平性意见,ACIC董事会根据GIO预期业务线的潜在未来价值,确定GIO的公平市场价值至少为截至业务合并协议签署之日在信托账户中持有的净资产(不包括在信托账户中持有的递延承销折扣,以及在信托账户上赚取的收入应缴纳的税款)的80%。
154
企业合并对ACIC股东的重大美国联邦所得税后果
下面的讨论是对我们的A类普通股持有者的某些美国联邦所得税考虑因素的总结,这些考虑因素涉及与批准企业合并有关的赎回权的行使。本概要依据的是经修订的1986年《国内税收法》(“法典”)、财政部颁布的条例、国内税收局(“IRS”)的现行行政解释和做法以及司法裁决,所有这些都是现行的,所有这些都可能有不同的解释或改变,可能具有追溯效力。不能保证IRS不会主张,或法院不会维持与下述任何税务考虑相反的立场。
本摘要并未讨论美国联邦所得税的所有方面,这些方面根据特定投资者的个人情况可能对他们很重要,例如:(i)受特别税收规则约束的投资者(例如,金融机构、保险公司、共同基金、养老金计划、S公司、经纪自营商、选择按市值计价的证券交易商、受监管的投资公司、房地产投资信托、信托和遗产、合伙企业及其合伙人以及免税组织(包括私人基金会),(ii)将持有A类普通股作为“跨式”、“对冲”、“转换”、“合成证券”、“建设性所有权交易”、“建设性出售”的一部分,或为美国联邦所得税目的而进行的其他综合交易,(iii)在符合《守则》第451(b)节适用的财务报表会计规则的情况下,(iv)在符合《守则》替代性最低税收规定的情况下,拥有美元以外功能货币的美国持有者(定义见下文),美国侨民,(v)实际或建设性地拥有ACIC百分之五或以上的A类普通股,以及(vi)非美国持有者(定义见下文,但下文另有讨论的除外),所有这些人都可能受到与下文概述的税收规则大不相同的税收规则的约束。此外,本摘要不讨论任何州、地方或非美国税收考虑因素、任何非所得税(如赠与税或遗产税)考虑因素、替代性最低税或联邦医疗保险税。此外,本摘要仅限于根据《守则》将我们的A类普通股作为“资本资产”(通常是为投资而持有的财产)持有的投资者。
如果一个合伙企业(包括在美国联邦所得税方面被视为合伙企业的实体或安排)持有我们的A类普通股,这种合伙企业中合伙人的税务待遇一般将取决于合伙人的地位、合伙企业的活动以及在合伙人一级作出的某些决定。如果您是持有我们A类普通股的合伙企业的合伙人,我们建议您就赎回的税务后果咨询您的税务顾问。
我们敦促我们的A类普通股持有人行使他们的赎回权,就美国联邦、州、地方、外国收入和其他税收后果咨询他们自己的税务顾问。
美国联邦所得税对美国持有者的考虑
本节针对的是ACIC A类普通股的美国持有者,他们选择将自己持有的ACIC A类普通股赎回为现金。就本讨论而言,“美国持有人”是这样赎回其ACIC A类普通股的受益所有人,并且是:
| ● | 美国公民或美国居民; |
| ● | 在美国、其任何州或哥伦比亚特区的法律中或根据其法律创建或组建的公司(包括在美国联邦所得税方面被视为公司的实体); |
| ● | 为美国联邦所得税的目的,其收入包括在总收入中的遗产,不论其来源如何;或 |
| ● | 信托(A)的管理受美国法院的主要监督,并有一名或多名美国人(在《守则》的含义内)有权控制信托的所有重大决定,或(B)根据适用的财政部条例进行了有效的选举而被视为美国人的信托(A)。 |
155
A类普通股的赎回
如果美国持有者的A类普通股被赎回,出于美国联邦所得税的目的,该交易的处理将取决于赎回是否符合《守则》第302条规定的A类普通股的出售条件。赎回是否符合出售处理条件,将主要取决于美国持有人持有的ACIC股票的总数(包括美国持有人因持有认股权证而推定拥有的任何股票)相对于赎回前后ACIC所有股票的总数。A类普通股的赎回通常将被视为A类普通股的出售(而不是分配),如果赎回(i)对美国持有人来说“严重不成比例”,(ii)导致美国持有人在美国的权益“完全终止”,或者(iii)对美国持有人来说“本质上不等同于股息”。下文对这些试验作了更全面的解释。
在确定上述任何一项测试是否满足时,美国持有者不仅要考虑美国持有者实际拥有的股票,还要考虑ACIC的股票中由其推定拥有的股票。除直接拥有的股票外,美国持有者还可以建设性地拥有美国持有者拥有权益或在该美国持有者中拥有权益的某些相关个人和实体拥有的股票,以及美国持有者有权通过行使期权获得的任何股票,期权通常包括根据行使认股权证可以获得的A类普通股。为了满足这一严重不成比例的标准,除其他要求外,在赎回A类普通股后,美国持有人实际和建设性地拥有的ACIC已发行有表决权股票的百分比,必须低于赎回前美国持有人实际和建设性地拥有的ACIC已发行有表决权股票的80%。如果(i)美国持有人实际和推定拥有的ACIC股票的所有股份被赎回,或者(ii)美国持有人实际拥有的ACIC股票的所有股份被赎回,并且美国持有人有资格根据特定规则放弃并实际上放弃某些家庭成员拥有的股票的归属,并且美国持有人不推定拥有任何其他股票,则美国持有人的权益将完全终止。如果美国持有人的转换导致美国持有人在ACIC的权益比例“显著减少”,那么A类普通股的赎回本质上将不等同于股息。赎回是否会导致美国持有人在ACIC的权益比例显著下降,将取决于具体的事实和情况。然而,美国国税局在一份已公布的裁决中表示,即使是对一家对公司事务没有控制权的上市公司的少数股东的权益比例小幅减少,也可能构成这种“有意义的减少”。
如果上述测试都不满足,那么赎回将被视为分配,其税收影响将如下面题为“美国联邦所得税对美国持有者的考虑——分配的税收”的小节中所述。
考虑行使赎回权的ACIC A类普通股的美国持有者应咨询自己的税务顾问,以确定根据《守则》,其A类普通股的赎回将被视为出售还是分配。
赎回被视为出售的A类普通股的收益或损失
如果赎回符合出售A类普通股的条件,美国持有者必须将任何收益或损失视为资本收益或损失。任何此类资本收益或损失将是长期资本收益或损失,如果美国持有人对如此处置的A类普通股的持有期超过一年。一般而言,美国持有者将确认收益或损失,其数额等于(i)在此类赎回中收到的现金数额之间的差额(或者,如果在处置时A类普通股作为单位的一部分持有,根据A类普通股当时的公允市场价值和该单位所包含的一份认股权证的一半)和(ii)美国持有人在其如此赎回的A类普通股中调整后的税基,在此类处置中实现的分配给A类普通股的部分。美国持有者在其A类普通股中调整后的税基通常等于美国持有者的收购成本(即在行使整份认股权证时获得的分配给A类普通股的单位购买价格的一部分,或美国持有者对A类普通股的初始基础)减去任何被视为资本回报的先前分配。非公司美国持有者实现的长期资本收益一般将按较低的税率征税。资本损失的扣除受到限制。
156
分配的课税
如果赎回不符合出售A类普通股的条件,美国持有者将被视为获得分配。一般而言,对美国持有者的任何分配都将构成美国联邦所得税的红利,但以根据美国联邦所得税原则确定的ACIC当期或累计收益和利润支付的红利为限。超过当期和累计收益和利润的分配将构成资本回报,将用于抵消和减少(但不低于零)美国持有者在ACIC A类普通股中的调整后税基。任何剩余的超额部分将被视为出售或以其他方式处置A类普通股所实现的收益,并将被视为上文题为“美国联邦所得税对美国持有者的考虑——赎回A类普通股的收益或损失被视为出售”的小节中所述的收益。如果满足必要的持有期,ACIC支付给作为应税公司的美国股东的股息通常将有资格获得所收到的股息扣除。除某些例外情况外,如果满足某些持有期要求,ACIC支付给非公司美国股东的股息通常将构成“合格股息”,将按较低的税率征税。
对非美国持有者的美国联邦所得税考虑
本节针对的是ACIC A类普通股的非美国持有者,他们选择将其A类普通股赎回为现金。就本讨论而言,“非美国持有人”是指赎回ACIC A类普通股的受益所有人(合伙企业除外),而不是美国持有人。
A类普通股的赎回
就美国联邦所得税而言,赎回非美国持有者的A类普通股的特征通常与美国联邦所得税对赎回美国持有者的A类普通股的特征相对应,如上文题为“美国联邦所得税对美国持有者的考虑”的小节所述。
考虑行使赎回权的ACIC A类普通股的非美国持有者应咨询自己的税务顾问,以确定根据《守则》,其A类普通股的赎回将被视为出售还是分配。
赎回被视为出售的A类普通股的收益或损失
如果赎回符合出售A类普通股的条件,非美国持有者一般无需就出售其A类普通股ACIC所确认的收益缴纳美国联邦所得税或预扣税,除非:
| ● | 该收益与非美国持有者在美国境内进行的贸易或业务有效相关(根据某些所得税条约,该收益可归属于非美国持有者维持的美国常设机构或固定基地),在这种情况下,非美国持有者在赎回时通常将受到与美国持有者相同的待遇,而非美国公司持有者可能需要按30%的税率(或适用的所得税条约可能规定的较低税率)缴纳分支机构利得税; |
| ● | 非美国持有者是指在赎回发生的纳税年度在美国停留183天或以上且满足某些其他条件的个人,在这种情况下,非美国持有者将对该个人当年的净资本收益征收30%的税;或 |
| ● | 就美国联邦所得税而言,ACIC是或曾经是一家“美国不动产控股公司”,在截至处置之日的五年期间或非美国持有者持有ACIC的A类普通股期间(以较短者为准)的任何时间,如果ACIC的A类普通股股票在一个成熟的证券市场上定期交易,非美国持有者直接或建设性地拥有,在处置前的五年期间或非美国持有人持有ACIC A类普通股的期间内的任何时间,ACIC A类普通股的5%以上。我们不认为ACIC是或曾经是一家美国房地产控股公司。 |
157
分配的课税
如果赎回不符合出售A类普通股的条件,非美国持有者将被视为获得分配。一般而言,ACIC向非美国持有者支付的ACIC A类普通股股份的任何分配,只要是从ACIC的当期或累计收益和利润(根据美国联邦所得税原则确定)中支付的,就构成美国联邦所得税目的的股息,如果此类股息与非美国持有者在美国境内进行的贸易或业务没有实际联系,ACIC将被要求从股息总额中按30%的税率预扣税款,除非该非美国持有人有资格根据适用的所得税条约获得较低的预扣税率,并提供适当的证明证明证明其有资格获得较低的税率。任何不构成股息的分配将首先被视为减少(但不低于零)非美国持有者在其所持ACIC A类普通股股份中的调整后税基,如果这种分配超过非美国持有者的调整后税基,则被视为出售或以其他方式处置A类普通股所获得的收益,这些收益将按照上文题为“对非美国持有者的美国联邦所得税考虑——出售、应税交换或其他应税处置A类普通股的收益”的小节进行处理。如果ACIC支付给非美国持有者的股息与该非美国持有者在美国境内进行的贸易或业务有实际联系,一般不需要缴纳美国预扣税,前提是该非美国持有者遵守某些认证和披露要求。相反,这类红利一般将按适用于美国持有者的相同累进个人或公司税率,在扣除某些扣除额后缴纳美国联邦所得税(适用的所得税条约可能规定的免税或减税)。如果非美国股东是一家公司,作为实际关联收入的股息也可能被征收30%的“分支机构利得税”(或适用的所得税条约可能规定的较低税率)。
如前所述,上述关于美国联邦所得税的某些重大后果的讨论仅供一般参考之用,并不旨在、也不应被解释为向任何股东提供法律或税务建议。我们再次敦促您咨询您自己的税务顾问,以确定收取现金以换取与业务合并有关的股份对您的具体税务后果(包括任何美国联邦、州、地方或外国收入或其他税法的适用和影响)。
预期会计处理
根据公认会计原则,该业务合并将作为反向合并入账。在这种会计方法下,ACIC将被视为财务报告目的的“被收购”公司,而GIO将是会计“收购方”。因此,业务合并将被视为相当于GIO为ACIC的净资产发行股票,同时进行资本重组。ACIC的净资产将按历史成本列报,不记录商誉或其他无形资产。
监管事项
企业合并和《企业合并协议》所设想的交易不受任何额外的联邦或州监管要求或批准,但《交易法》第14a-12条规定的企业合并和招标材料备案除外。
评估权
ACIC的股东不享有与DGCL下的业务合并有关的评估权。
批准须经表决
企业合并提案的批准需要获得在特别会议上投票的ACIC普通股多数股份持有人的赞成票。
业务合并提案的条件是每一项所需提案获得批准。因此,如果所需提案未获批准,即使获得ACIC股东的批准,企业合并提案也不会产生任何效果,企业合并也不会完成。
行政协调会理事会的建议
ACIC董事会建议ACIC股东投票赞成BUSINESS COMBINATION PROPOSAL。
158
提案2:NTA提案
一般
正如这份代理声明/招股说明书的其他部分所讨论的,ACIC要求其股东批准NTA提案。如果NTA提案获得批准和实施。在拟议的业务合并完成之前,将对现行《宪章》作出下列修正:
| (a) | 现行章程第9.2(a)条应全部删除,改为:“在首次业务合并完成之前,公司应向所有发售股份持有人提供机会,在首次业务合并完成后,根据第9.2(b)和9.2(c)条并在受其限制的情况下,赎回其发售股份(该等持有人有权根据该等条文赎回其发售股份)”赎回权")的现金,相当于根据本条例第9.2(b)条所厘定的适用的每股赎回价格赎回价格”).即使本经修订及重订的证明书内有任何相反的规定,根据发售发出的任何认股权证并无任何赎回权或清盘分配。" |
| (b) | 现行章程第9.2(i)条应全部删除,代之以以下文字:“如果公司提出赎回发行股份,同时股东对初始业务合并进行投票,公司应完成拟议的初始业务合并,但前提是该初始业务合并获得在为审议此类初始业务合并而召开的股东会议上投票的普通股多数股份持有人的赞成票。” |
| (c) | 现行《宪章》第9.2(e)条应全部删除。 |
| (d) | 《现行章程》第9.7节应删除以下文字:“但是,如果任何希望赎回的股东因赎回限制而无法赎回,则任何此类修订将作废,且第九条将保持不变。” |
修订的理由
ACIC股东被要求在交易结束前通过拟议的《现行章程》修正案,ACIC董事会认为,这可能有助于完成业务合并。目前的章程限制了ACIC完成初始业务合并的能力,或者在初始业务合并时赎回ACIC A类普通股的能力,如果这会导致ACIC的有形资产净值低于5,000,001美元的话。如果有重大的赎回请求,使ACIC的有形资产净值在企业合并完成时低于5000,001美元,则现行章程将阻止ACIC完成企业合并,即使所有其他完成条件都得到满足。如果企业合并完成,则经NTA修正案修订的现行章程将在企业合并完成时全部由拟议章程取代,而本委托书/招股说明书中所有提及“现行章程”的内容均应被视为是指经修正案修订的现行章程。
批准须经表决
NTA提案的批准需要持有ACIC普通股多数流通股的股东投赞成票。
NTA提案的条件是业务合并提案获得批准。因此,如果企业合并提案未获批准,那么NTA提案将不会产生任何影响,即使获得ACIC股东的批准。
行政协调会理事会的建议
ACIC董事会建议ACIC股东对NTA提案投“赞成”票。
159
建议3:《宪章》建议
概述
关于企业合并,ACIC请ACIC的股东考虑并投票表决一项提案,以经修订和重述的公司注册证书(“拟议章程”)取代现行章程,其形式基本上与本代理声明/招股说明书附件B所附的一样,在企业合并完成后生效(“章程提案”)。
建议经修订及重订的公司法团证明书
下表概述了拟议在现行《宪章》和拟议《宪章》之间作出的主要修改。本摘要以《现行章程》全文、《拟议章程》全文(其副本作为附件B附在本委托书/招股说明书后)和《拟议章程》全文(其副本作为附件C附在本委托书/招股说明书后)为限。我们鼓励所有股东阅读《现行章程》、《拟议章程》和《拟议章程》全文,以更完整地描述其条款。
规定 |
|
现行宪章 |
|
拟议宪章 |
|---|---|---|---|---|
董事的免职 |
在符合《现行章程》第5.5条的规定下,任何董事或所有董事可随时被免职,但仅限于因由,且只有在有权在董事选举中作为单一类别共同投票的ACIC当时所有已发行股本的多数表决权持有人投赞成票的情况下。 见《现行宪章》第五条第5.4节。 |
根据一个或多个已发行系列优先股的持有人选举董事的特殊权利,合并公司董事会或任何个别董事可在任何时候被免职,但仅限于因故,且只有在合并公司当时有权在董事选举中投票的所有已发行有表决权股份的至少三分之二(66%和2/3%)的持有人投赞成票的情况下。 见《拟议宪章》第五条C节。 |
||
股东行动 |
根据任何已发行系列优先股的持有人的任何权利和适用法律的要求,ACIC股东特别会议只能由ACIC董事会主席、ACIC首席执行官或ACIC董事会根据ACIC董事会过半数通过的决议召开,ACIC股东召开特别会议的权利在此被明确拒绝。除非根据《现行章程》(包括任何优先股的指定)另有规定,或根据《现行章程》另有规定,涉及任何已发行的优先股系列的持有人的权利,在首次公开发行完成后,ACIC的股东必须采取或允许采取的任何行动,必须由ACIC的股东正式召集的年度会议或特别会议作出。 |
在符合一系列或多于一系列优先股的持有人的特别权利的规定下,合并公司股东特别会议在任何时间只可由合并公司董事会、合并公司董事会主席、行政总裁或总裁或在合并公司董事会主席、行政总裁或总裁的指示下为任何目的而召开,不得由任何其他人或其他人召集。在任何股东特别会议上所处理的事务,应限于与会议通知中所述的目的有关的事项。 见《拟议宪章》第六条。 |
160
规定 |
|
现行宪章 |
|
拟议宪章 |
|---|---|---|---|---|
股东,并不能通过股东的书面同意而生效,但可以通过书面同意对我们的B类普通股采取行动的股东除外。 见现行《宪章》第七条。 |
||||
宪章修正案 |
ACIC保留随时和不时修改、更改、更改或废除现行宪章中所载的任何条款(包括任何优先股的指定)以及当时有效的特拉华州法律授权的其他条款的权利,这些条款可以按照现行宪章和DGCL现在或以后规定的方式添加或插入;除第八条规定的情况外,本文赋予股东的所有权利、优惠和特权,无论其性质如何,董事或任何其他人士,根据现行章程或经修订后的章程,在符合本XI所保留的权利的情况下,获授予董事或任何其他人士;但现行章程第九条只可按本章程的规定予以修订。 见现行《宪章》XI。 |
拟议的《宪章》可在特拉华州法律允许的情况下进行修订。 尽管《拟议章程》中有任何相反的规定,但除适用法律要求的任何表决外,《拟议章程》中的下列条款可全部或部分修改、更改、废除或撤销,或任何与之不一致的条款,只有在合并后公司所有当时有权投票的未发行股票的总投票权的三分之二(66%和2/3%)以上的持有人作为单一类别共同投票的情况下,方可予以通过,第五条(董事会)、第六条(股东)、第七条(责任)、第八条(赔偿)、第九条(某些诉讼的排他性诉讼)和第十条(修正案) 见《拟议宪章》第十条。 |
||
公司名称 |
Apeiron Capital Investment Corp. 见现行《宪章》第一条。 |
GIO世界健康控股有限公司。 见《拟议宪章》第一条。 |
||
空白支票公司的特定规定和企业合并前股份权利的变更 |
现行《章程》第九条载有与企业合并有关的机械和后勤方面的规定,这些规定不得修改,除非获得当时ACIC所有已发行普通股的多数股东的赞成票。 |
拟议章程不包括空白支票公司条款或在企业合并之前适用的其他条款,如现行章程第九条,因为在企业合并完成后,合并后的公司将不是空白支票公司。 |
||
现行章程还包含第四条第4.5节的条款,旨在为ACIC的普通股股东提供某些权利和保护。凡某一类股份的全部或任何权利因分为不同类别的股份而更改,则任何该等更改只可在 |
拟议的《宪章》中没有相应的规定。 |
161
规定 |
|
现行宪章 |
|
拟议宪章 |
|---|---|---|---|---|
该类别已发行股份的多数股东的书面同意。 见现行《宪章》第九条和第四条第4.3节。 |
||||
普通股;优先股 |
ACIC的现行章程授权111,000,000股,包括(a)110,000,000股普通股,包括(i)100,000,000股A类普通股和(ii)10,000,000股B类普通股,以及(b)1,000,000股优先股。 见现行《宪章》第四条。 |
拟议章程将规定将法定股本从505,000,000股增加,包括(一)500,000,000股普通股和(二)5,000,000股优先股。 见《拟议宪章》第四条。 |
合并公司附例
此外,以下是拟议附例的摘要。本摘要以建议附例全文为限,该附例的副本作为附件C附于本代理声明/招股章程内。我们鼓励所有股东阅读附例全文,以更完整地描述其条款。
所有股东会议均应在合并公司董事会、合并公司董事会主席或首席执行官不时指定的特拉华州内外地点举行,如未指定,则应在GIO的主要办公室举行,但合并公司董事会可自行决定会议不在任何地点举行,而只能通过远程通讯方式举行。
除适用法律、拟议章程或拟议章程另有规定外,在每一次股东大会上,GIO已发行和未发行的股本中拥有多数表决权并有权在会上投票的股份的持有人,如亲自出席或由代理人代表出席,即构成在该次股东大会上进行业务交易的法定人数。任何股东大会可不时延期至任何其他时间,并可延期至根据本附例可举行股东大会的同一地点或其他地点,由合并公司董事会、该会议的主席,或在该会议的主席指示下,由出席该会议或有代表出席该会议并有权就该会议投票的股东所投的多数票(但少于法定人数)进行表决。在延期的股东大会上,合并后的公司可以处理原股东大会上可能处理的任何事务。
有权在股东大会上投票的每一登记在册的股东可以亲自投票,也可以授权另一人通过代理人为该股东投票。股东可授权另一人或多人代表该股东作为代理人,方法是将电子传输传送或授权传送给将作为代理持有人的人,或传送给将作为代理持有人的人正式授权接收此种传输的代理招标公司、代理支持服务组织或类似的代理人,但任何此类电子传输必须载明或提交信息,从中可以确定该电子传输是由股东授权的。授权另一人或多于一人代表股东行事的书面或传送的任何副本、传真电讯或其他可靠复制品,可代替或使用该书面或传送的原件,用于该书面或传送原件可用于的任何及所有目的;但该等副本、传真电讯或其他复制品须为该书面或传送原件的完整复制品。除其中另有限制外,代理人应使获授权的人有权在该会议的任何休会期间投票。代理人应向合并后公司的秘书备案。除非该代理人明确规定较长的期限,否则自该代理人之日起三年后,不得对该代理人进行表决。代理人可以是不可撤销的,如果它声明它是不可撤销的,并且只有当它与法律上足以支持不可撤销权力的利益相结合时,才可以是不可撤销的,而不论与它相结合的利益是对股票本身的利益,还是对合并后公司的一般利益。股东可藉亲自出席会议及投票,或向合并后公司的秘书提交书面文书,撤销任何不可撤销的代表,或向合并后公司的秘书提交一份书面文书,以撤销该代表或另一份已妥为签立、日期较后的代表。
公司的业务及事务须由合并公司董事会管理或在合并公司董事会的指示下管理,合并公司董事会可行使公司的所有该等权力,但法律、拟议章程或拟议章程另有规定的除外
162
附例。董事不必是特拉华州的股东或居民。组成合并后公司董事会全体的董事人数,应完全由合并后公司董事会不时通过的一项或多项决议决定。合并公司董事会的任何空缺,即使少于法定人数,也应由当时在任的董事过半数投赞成票填补。只有按照下列程序被提名的人才有资格被选为公司董事,但一个或多个系列优先股的条款对一个或多个系列优先股的持有人选举董事的权利另有规定的除外。除任何其他适用的规定外,如要由股东作出提名,该股东必须已以适当的书面形式及时通知秘书。为及时起见,股东向秘书发出的提名通知,必须由秘书在公司的主要行政办公室收到(i)如属周年会议,则不得迟于紧接前一次股东周年会议的周年日期前第90天的营业时间结束,亦不得早于紧接前一次股东周年会议的周年日期前第120天的营业时间结束;但如该周年会议在周年日期前30天或后70天以上,股东必须在不早于会议召开前第120天的营业时间结束前,以及不迟于(A)会议召开前第90天或(B)公司首次公开宣布年会召开日期的翌日的第10天(以较晚者为准),才能及时收到通知;及(ii)如属为选举董事而召开的股东特别会议,但须在合并后公司的会议通知所列的特别会议上选举董事,并须进一步规定股东所作的提名是在会议通知所列的将在该特别会议上填补的董事职位之一,不早于该特别会议召开前的第120天,且不迟于(x)该特别会议召开前的第90天及(y)首次公开披露选举董事的该特别会议召开日期的翌日的第10天的营业时间结束。
(a)在任何时间任职的过半数董事和(b)合并公司董事会根据拟议的附例第2.2节设立的董事人数的三分之一中的较大者,即构成合并公司董事会的法定人数。如合并公司董事会的任何会议的法定人数不足,则出席会议的过半数董事可不时休会,而无须另行通知,但会议公告除外,直至达到法定人数为止。
合并公司董事局可指定一个或多于一个委员会,由一名或多于一名公司董事组成,该委员会具有合并公司董事局因此而赋予的合法可转授的权力及职责,由合并公司董事局乐意服务。合并公司董事会可指定一名或多于一名董事为任何委员会的候补成员,该候补成员可在该委员会的任何会议上接替任何缺席或丧失资格的成员。在委员会成员缺席或丧失资格的情况下,出席任何会议但未被取消投票资格的委员会成员,不论该成员是否构成法定人数,均可一致委任合并公司董事会的另一名成员,以代替任何该等缺席或丧失资格的成员出席会议。任何该等委员会,在合并公司董事会决议所规定的范围内,并在符合法律条文的规定下,拥有并可行使合并公司董事会在管理合并公司的业务及事务方面的所有权力及权力,并可授权在所有可能需要该委员会的文件上加盖合并公司的印章。各该等委员会须备存会议纪录及作出合并公司董事会不时要求的报告。除拟议附例的拟议章程或合并公司董事会指定委员会的决议另有规定外,委员会可设立一个或多个小组委员会,每个小组委员会由委员会的一名或多名成员组成,并将委员会的任何或全部权力及权力转授予小组委员会。合并公司的高级人员由合并公司董事会选出,包括一名行政总裁、一名总裁、一名首席财务官、一名司库和一名秘书。合并公司董事会亦可酌情根据拟议的附例选举一名或多名副总裁、助理司库、助理秘书及其他高级人员。
除非合并公司董事会指定另一人为合并公司的首席执行官,总裁应为合并公司的首席执行官。行政总裁须在合并公司董事会的指示下,全面负责及监督合并公司的业务,并须执行行政总裁职位所常发生的一切职责及权力,或由合并公司董事会转授予该人员的一切权力。总裁须执行合并公司董事会或行政总裁(如总裁并非行政总裁)不时订明的其他职责及权力。如果首席执行官或总裁(如果总裁不是首席执行官)缺席、不能履行或拒绝履行职责,副总裁(如果有多名副总裁,则由合并后的公司董事会确定的副总裁)应履行首席执行官的职责,在履行这些职责时,应拥有首席执行官的所有权力,并受对首席执行官的所有限制。
163
经选举产生的公司高级职员须由合并公司董事会委任,并须任职至合并公司董事会妥为选出其继任人并使其符合资格为止,或直至其较早前去世、辞职或被免职为止。由合并公司董事会选出的任何人员,可随时由合并公司董事会罢免,不论是否有因由。
合并公司的股份须以证明书表示;但合并公司董事会可藉决议或决议规定,任何类别或系列的部分或全部股份须为无证明股份,而该等股份可由该等股份的登记官维持的簿记系统作为证明。
在适用法律允许的最大限度内,合并后的公司应按照拟议章程和拟议章程中规定的条款,对这些人进行赔偿,使其免受伤害,并预支这些费用。本拟议章程赋予任何受偿人的获得赔偿和预支费用的权利,不应排除任何受偿人根据适用法律、拟议章程、拟议章程、协议、股东或无利害关系董事的投票或其他方式可能拥有或以后获得的任何其他权利。合并后的公司可自掏腰包购买和维持保险,以保护自己或公司或其他公司、合伙企业、合资企业、信托或其他企业的任何董事、高级职员、雇员或代理人免受任何费用、责任或损失,无论公司是否有权根据DGCL就该等费用、责任或损失向该人作出赔偿。
批准须经表决
批准《章程》提案需要获得ACIC普通股已发行股票多数持有者的赞成票。
章程提案的条件是企业合并提案获得批准。因此,如果企业合并提案未获批准,即使ACIC的股东批准,章程提案也不会产生任何效果。宪章提案不以单独核准组织文件提案为条件。
行政协调会理事会的建议
ACIC董事会建议ACIC股东对《宪章》提案投“赞成”票。
164
提案4-9:组织文件提案
概述
关于企业合并,ACIC要求ACIC的股东在不具约束力的咨询基础上,就批准拟议章程中某些治理条款的提案进行投票。这些单独的投票不是特拉华州法律的其他要求,因此是咨询投票,对ACIC或ACIC董事会没有约束力。此外,业务合并不以单独核准组织文件提案为条件。
因此,假定《宪章》提案获得核准,行政协调会打算在会议结束时通过《宪章》提案,而不论对组织文件提案的非约束性咨询表决结果如何。
建议4
ACIC的股东被要求批准《拟议章程》中的条款,规定董事只能因故被罢免,而且必须获得至少66名股东的赞成票。2∕3有权在选举董事时作为单一类别共同投票的公司所有当时已发行的股票的投票权的百分比。
建议5
ACIC的股东被要求批准拟议章程中的条款,规定(i)股东特别会议只能由合并公司董事会根据合并公司董事会多数成员或合并公司秘书通过的决议召集,在收到股东特别会议的一份或多份书面要求后,合并公司董事会应召集股东特别会议,合并后公司已发行股份的至少25%的投票权和(ii)股东只能在年度会议和特别会议上采取行动,而不是通过书面同意。
建议6
ACIC的股东被要求批准拟议章程中的条款,规定拟议章程中某些条款的修订与董事人数和董事任期有关,并且拟议章程的任何修订都需要至少66名股东的赞成票2∕3有权就该修订投票的公司当时已发行股本的投票权的百分比。
提议7
ACIC的股东被要求批准拟议章程中的条款,将合并后公司的公司名称改为“GIO World Health Holdings,Inc”。
提议8
ACIC的股东被要求批准一些条款,使合并后的公司永久存续,而不是要求ACIC在IPO结束后21个月解散和清算,这些条款将被纳入拟议章程,以删除某些仅适用于空白支票公司的条款,这些条款在企业合并完成后将不再适用。
提议9
ACIC的股东被要求批准拟议章程中的条款,将所有类别股票的授权股份总数增加到260,000,000股,每股面值为0.0001美元,包括(i)250,000,000股普通股和(ii)10,000,000股优先股。
165
批准组织文件提案的理由
主任免职
现行《宪章》和拟议《宪章》都规定了一个分类的董事会,这样每年只选出一部分董事。拟议章程还规定,董事只有在至少66名股东的赞成票下才能因故被免职2∕3有权在董事选举中普遍投票的公司所有当时已发行的股本股份的投票权的百分比。ACIC董事会认为,绝对多数票的要求将(一)增加董事会的连续性,增加熟悉公司业务运作的经验丰富的董事会成员在任何特定时间担任董事会成员的可能性,以及(二)使潜在收购者或其他人、集团或实体更难获得合并后公司董事会的控制权。
召集股东会议;股东以书面同意的方式采取行动
ACIC董事会认为,合并后的公司董事会或某些高管应召开股东特别会议,以使潜在收购者或其他人、集团或实体更难控制合并后的公司董事会。
宪章修正案
要求(i)至少有66名股东投赞成票2∕3有权就修订建议章程中有关董事人数及董事任期及附例修订的某些条文,以及(ii)持有至少66份股份的股东的赞成票,就该等修订投票的公司当时已发行股本股份的投票权的百分比2∕3股东修订附例的目的是保护拟议章程及附例的主要条文不受任意修订,并防止简单多数股东采取可能对其他股东有害的行动或修改旨在保护所有股东的条文。
公司名称
ACIC董事会认为,将合并后的公司名称改为“GIO World Health Holdings,Inc.”是可取的,以反映合并后的业务和未来的合并业务。
空白支票公司
ACIC董事会已决定,取消与ACIC作为空白支票公司的地位相关的条款,包括章程提案中强调将被删除的具体条款,符合合并后公司的最佳利益。这种消除是可取的,因为这些规定在业务合并完成后将不适用。
法定股本
ACIC董事会认为,合并后的公司必须有足够数量的普通股和优先股可供发行,以促进业务合并所设想的交易,以支持合并后公司的增长,并为未来的公司需要提供灵活性,并与奖励计划下的未来股权赠款有关。
166
批准须经表决
每一项组织文件提案的批准都需要获得ACIC普通股已发行股票多数持有者的赞成票。
如上所述,组织文件提案是咨询投票,因此对行政协调会或行政协调会理事会没有约束力。此外,业务合并并不以单独核准组织文件提案为条件(除核准《宪章》提案外,还应单独核准这些提案)。因此,假定《宪章》提案获得核准,行政协调会打算在会议结束时通过《宪章》提案,而不论对组织文件提案进行的不具约束力的咨询表决结果如何。
委员会的建议
ACIC董事会建议ACIC股东投票“赞成”批准每一份组织文件提案。
167
Proposal 10:The Incentive Plan Proposal
概述
审议并投票通过一项提案,以批准并通过GIO World Health Holdings,Inc. 2023股权激励计划,该计划在此称为“激励计划”,其形式作为附件D附于本委托书/招股说明书(该提案称为“激励计划提案”)。
ACIC董事会打算通过该激励计划,但须获得ACIC股东的批准。
如果该激励计划获得ACIC股东的批准,那么该激励计划将在企业合并完成后生效。
如果该激励计划未获得ACIC股东的批准,该计划将不会生效,也不会根据该计划授予任何奖励。
奖励计划摘要
以下是激励计划的主要特点摘要。本摘要全文以《激励计划》全文为准,其形式载于本委托书/招股说明书附件D。
目的
奖励计划的目的是:(a)通过与合并后公司的目标相一致的短期和长期奖励,鼓励合并后公司的盈利能力和增长;(b)鼓励参与者在个人业绩方面表现优异;(c)促进参与者之间的团队合作;(d)在吸引和留住关键员工、董事和顾问方面给予合并后公司显着的优势。
资格
有资格参加奖励计划的人员将是合并后公司及其子公司的雇员、非雇员董事和顾问,这些顾问由计划管理人酌情决定不时选定,包括未来雇员、非雇员董事和顾问。在该个人的开始日期之前授予该前景的任何奖励不得归属或行使,在该个人首次开始在合并公司或其子公司提供服务的日期之前,不得向该个人发行任何股份。截至本代理声明/招股说明书之日,大约有三人将有资格参加奖励计划,其中包括大约两名雇员和一名非雇员董事。
行政管理
奖励计划将由合并公司董事会的薪酬委员会、合并公司董事会或其他类似委员会根据奖励计划的条款管理。计划管理人最初将是合并后公司董事会的薪酬委员会,将有充分的权力从有资格获得奖励的个人中选择将获得奖励的个人,对参与者做出任何组合奖励,并根据奖励计划的规定决定每项奖励的具体条款和条件。计划管理人可将授予不受《交易法》第16条报告和其他规定约束的个人的授予权授予合并后公司的一名或多名管理人员。计划管理人作出的所有决定应是最终的、结论性的,并对所有人,包括合并公司和参与者具有约束力。
股份储备
根据激励计划可发行的合并后公司普通股的股份数量,等于合并完成后(赎回生效后)已发行和流通的合并后公司普通股股份总数的10%。激励计划下的所有股票可在激励股票期权行使时发行。
168
根据该激励计划,可供发行的股票数量还将包括在每个日历年的第一个交易日(从2024日历年开始,到2033日历年结束)自动每年增加相当于上一个日历年最后一天已发行和未发行的合并公司普通股总数[ •]%的股票数量。尽管有上述规定,计划管理人仍可在某一年的1月1日之前采取行动,规定该年度的股份储备不会增加,或该年度的股份储备增加的股份数目较少。
根据激励计划可发行的股票可以是授权的,但未发行的,或重新获得的合并公司普通股。
激励计划下的任何奖励所依据的股份,如被没收、注销、在未发行股票的情况下得到满足或以其他方式终止(行权除外),将被重新纳入激励计划下可供发行的股份,并在《守则》第422条及其颁布的法规允许的范围内,作为激励股票期权发行的股份。尽管有上述规定,激励计划下的任何奖励所依据的股份,如被扣缴以支付税款或任何适用的行使价格,则该等股份应被视为已根据激励计划发行,不得根据激励计划发行。
169
对非雇员董事的奖励的年度限制
该奖励计划载有一项限制,根据该奖励计划的所有奖励以及合并后公司向任何非雇员董事支付的所有其他现金报酬的价值在任何历年不得超过500,000美元。
奖项类型
该激励计划规定授予股票期权、股票增值权、限制性股票、限制性股票单位、基于其他股票的奖励、基于其他现金的奖励,以及上述奖励的任何组合或集体奖励。除非个别授标协议另有规定,每项授标应在三年期间内授予,其中三分之一(1/3)的授标在授标日期的第一个周年日授予,其余的授标在其后每月授予。
股票期权
激励计划允许根据《守则》第422条的规定,授予购买合并后公司普通股股票的期权,以符合激励股票期权的条件,以及不符合激励股票期权的条件。根据激励计划授予的期权,如果不符合激励股票期权的条件或超过激励股票期权的年度上限,则为不合格期权。激励股票期权只能授予合并后公司及其子公司的员工。任何有资格根据奖励计划获得奖励的人士,均可获授不受限制的期权。
每份期权的期权行使价格将由计划管理人确定,但一般不得低于授予日合并后公司普通股公允市场价值的100%,如果激励股票期权授予10%的股东,则不得低于该股票公允市场价值的110%。每份期权的期限将由计划管理人确定,自授予之日起不得超过十(10)年(或授予10%股东的激励股票期权的期限为五年)。计划管理人将决定在什么时候或什么时间可以行使每一种选择,包括加速这种选择的归属的能力。
在行使期权时,期权行使价必须以现金、支票、现金等价物或交付(或证明所有权)由期权持有人不受限制地实益拥有或在公开市场购买的合并公司普通股股份的方式全额支付。在不违反适用法律的情况下,行使价格也可以通过经纪人协助的无现金行使来确定。此外,计划管理人可允许使用“净行权”安排来行使不合格的期权,这种安排将向期权持有人发行的股票数量减少最大数量的股票,其公允市场价值不超过总行权价格。
股票增值权
计划管理人可授予股票增值权,但须符合其所决定的条件和限制。股票增值权使接受者有权获得合并后公司的普通股,即现金,相当于合并后公司股价相对于行权价的增值价值。价格一般不得低于授予日合并后公司普通股公允市场价值的100%。每份股票增值权的期限由计划管理人确定,自授予之日起不得超过十年。计划管理人将决定在什么时间或时间可以行使每一股票增值权,包括加速这种股票增值权归属的能力。
受限制股份
计划管理人可根据其可能决定的条件和限制,将合并公司普通股的限制性股票授予参与者。这些条件和限制可能包括实现某些业绩目标或在指定的归属期内继续受雇于合并后的公司。除非在适用的授标协议中另有规定,参与人一般应享有股东对此类限制性股票的权利和特权,包括但不限于此类限制性股票的投票权和收取股息的权利(如适用)。
限制性股票单位
计划管理人可授予限制性股票单位,即在达到计划管理人规定的某些条件后,有权在未来某一日期按照授予条款获得合并公司普通股的股份。限制或条件可包括但不限于实现业绩目标、连续服务
170
与合并后的公司或其附属公司、时间的流逝或其他限制或条件。计划管理人决定受限制股份单位的授予者、受限制股份单位的授予者数目、受限制股份单位的授予者可被没收的时间、归属时间表和加速授予权,以及受限制股份单位授予者的所有其他条款和条件。受限制股份单位的价值可由计划管理人决定,以合并后的公司普通股、现金、其他证券、其他财产或上述各项的组合支付。
持有限制性股票单位的参与者作为合并后公司的股东将没有投票权。计划管理人可向参与人授予等值的股息权利,使接受者有权获得股息抵免额,如果接受者持有特定数量的合并公司普通股,则将支付股息抵免额。在分配之前,任何等值股息应受到与其所附的限制性股票单位相同的条件和限制。
其他基于股份的奖励
计划管理人可向任何参与者授予或出售一项权利或其他权益,该权利或权益可参照合并公司普通股,包括非限制性普通股或等值股息,以其计价或支付、全部或部分估值或以其他方式基于或与之相关。
其他现金奖励
计划管理人可根据激励计划授予现金奖励,包括作为奖金或在达到某些绩效目标时授予现金奖励。
资本Structure的变化
激励计划要求计划管理人对受激励计划约束的合并公司普通股的股份数量、激励计划中的某些限制以及任何尚未兑现的奖励做出适当调整,以反映股票股息、股票分割、特别现金股息和类似事件。
控制权变更
除根据奖励计划发出的授标协议所规定的情况外,如发生控制权变更(如奖励计划所界定的),每项未行使的股票奖励(已归属或未归属)将按计划管理人的决定处理,其中可包括:(a)合并公司继续进行该等未偿付的股票奖励(如合并公司是存续的法团);(b)存续的法团或其母公司承担该等未偿付的股票奖励;(c)存续的法团或其母公司以同等的奖励取代该等股票奖励;(d)就控制权价格的变动结算任何奖励(在适用范围内减去任何行使价格),或,如果行权价格等于或超过控制权价格的变化,或者如果计划管理人确定该奖励不能根据其条款合理归属,则该奖励应终止并被取消,不予考虑。
扣缴税款
奖励计划的参与者负责支付法律要求合并后的公司或其子公司在行使期权或股票增值权或授予其他奖励时扣缴的任何联邦、州或地方税款。计划管理人可促使合并公司或其附属公司的任何预扣税款义务全部或部分由适用实体履行,该实体将根据一项裁决,从合并公司普通股的股份中预扣若干股份,这些股份的合计公允市场价值将满足所应预扣的数额。计划管理人还可要求合并公司或其子公司的任何预扣税款义务全部或部分通过一项安排得到履行,根据该安排,根据任何裁决发行的一定数量的股票立即出售,并将出售所得汇给合并公司或其子公司,其数额将足以满足应付的预扣税款。经计划管理人批准,参与人可以通过交付(或证明所有权)由参与人不受限制地实益拥有或在公开市场上购买的合并公司普通股的股份来满足扣缴要求。
171
授标的可转移性
激励计划一般不允许转让或分配奖励,除非是通过遗嘱或世系和分配法律;但是,计划管理人有权允许参与者转让奖励(激励股票期权除外)。
任期
激励计划将在ACIC董事会通过后生效,除非提前终止,否则激励计划将继续有效十(10)年。
修订及终止
计划管理人可以修改或终止奖励计划,计划管理人可以修改或取消尚未支付的奖励,但未经持有人同意,此类行动不得对奖励下的权利产生重大不利影响。对激励计划的某些修订将需要获得合并后公司股东的批准。一般而言,未经股东批准,(i)本激励计划的任何修订或修改不得降低任何股票期权或股票增值权的行权价格,(ii)计划管理人不得取消任何未行使的股票期权或股票增值权,如果该股票期权或股票增值权所依据的普通股的公允市场价值低于其行权价格,并以新的期权或股票增值权取而代之,另一项奖励或现金,以及(iii)计划管理人不得采取任何其他根据适用的证券交易所的股东批准规则被视为“重新定价”的行为。
补偿政策
根据奖励计划授予的所有奖励将由合并后的公司根据适用的法律和公司政策(无论何时通过)予以削减、补偿、收回或收回,无论这些政策是否旨在满足《多德-弗兰克华尔街改革和消费者保护法》、《萨班斯-奥克斯利法》或其他适用的法律以及任何实施条例和/或上市标准的要求。
表格S-8
在企业合并完成后,在SEC规则允许的情况下,合并后的公司打算在S-8表格上向SEC提交一份登记声明,涵盖根据激励计划可发行的合并后公司普通股的股份。
美国联邦所得税的某些方面
以下是根据《激励计划》的现行规定和根据《激励计划》颁布的条例,对某些奖励的主要美国联邦所得税后果的概述。关于这种裁决的税务处理的规则是相当技术性的,因此下面关于税务后果的讨论必然是一般性的,并不完整。此外,法律规定及其解释可能会发生变化,其适用可能因具体情况而有所不同。本摘要没有描述激励计划下的所有联邦税收后果,也没有描述州或地方税收后果。
奖励计划不符合《守则》第401(a)节的规定,也不受经修订的1974年《雇员退休收入保障法》的任何规定的约束。合并后公司能否实现下述任何税收减免的好处,取决于合并后公司产生的应税收入以及合理化要求和合并后公司纳税申报义务的履行情况。
激励股票期权。期权持有人在授予或行使激励股票期权时一般不会实现应纳税所得额。如果在授予之日起两年后和行使之日起一年后出售或转让根据行使激励股票期权而发行给期权持有人的合并公司普通股股份,则通常而言(i)在出售这些股份时,超过期权行使价格(为股票支付的金额)的任何变现金额将作为长期资本收益向期权持有人征税,遭受的任何损失将是长期资本损失,(ii)合并后的公司或其附属公司均无权为联邦所得税目的而获得任何扣除;但此种激励股票期权必须符合激励股票期权的所有技术要求。激励股票期权的行使将产生一项
172
税收优惠,这可能会导致选择权人承担替代的最低纳税义务。如果在行使激励股票期权时获得的合并公司普通股在上述两年和一年持有期到期之前被处置(“取消资格处置”),通常(i)被处置人在处置当年将实现普通收入,其数额等于合并公司普通股在行使时的公平市场价值(如果有的话)超过其期权行使价格的部分(如果有的话),或者减去出售合并公司普通股所实现的数额,(ii)合并公司或其附属公司将有权扣除该等款额,而(iii)任何在行使时超过合并公司普通股股份的公平市价而变现的款额,将有资格获得资本收益待遇。如果激励股票期权的全部或部分行权价格以合并后公司普通股的形式支付,将适用特别规则。
如果一项激励股票期权在其不再符合上述税务处理条件时被行使,则该期权被视为不符合条件的期权。一般而言,如果激励股票期权在终止雇佣关系后超过三个月(或在因残疾而终止雇佣关系的情况下超过一年)行使,则不符合上述税收待遇。在因死亡而终止雇用的情况下,三个月规则不适用。
不合格的选择。在授予不合格期权时,期权持有人一般不会实现任何收入。一般而言,(i)在行使时,期权持有人实现的普通收入相当于期权行使价格与合并后公司普通股在行使日的公允市场价值之间的差额,合并后公司获得相同数额的税收减免;(ii)在处置时,行使日之后的升值或贬值视合并后公司普通股的持有时间长短被视为短期或长期资本收益或损失。特别规则将适用于不合格期权的全部或部分行使价通过投标合并公司普通股支付的情况。在行使期权时,期权持有人还需就公允市场价值超过期权行使价格的部分缴纳适用的社会保障税和联邦医疗保险税。
股票增值权,限制性股票,限制性股票单位,其他基于股票的奖励,以及其他基于现金的奖励。对于奖励计划下的所有其他奖励,合并后的公司或其子公司一般将有权获得相当于参与者在确认此类收入时实现的普通收入的税收减免。参与者通常需要缴纳普通所得税,并在裁决被行使、归属或不可没收时确认此类税收,除非裁决规定延期结算。
参与人在随后处置从股票增值权、限制性股票、限制性股票单位或其他基于股票的奖励中获得的合并公司普通股时确定收益或损失的依据,将是为这些股份支付的金额加上合并公司普通股股份最初交付时确认的任何普通收益,参与人持有这些股份的资本收益期限将从这些股份转让给参与人的次日开始。
降落伞支付。由于发生控制权变更(例如出售事件)而加速授予的任何部分的归属,可能导致与此种加速授予有关的全部或部分付款被视为《守则》所定义的“降落伞付款”。合并后的公司或其子公司可能无法全部或部分扣除任何此类降落伞付款,并可能对收款人的全部或部分此类付款(以及通常应缴纳的其他税款)征收不可扣除的20%联邦消费税。
第409A节。上述描述假定《守则》第409A条不适用于奖励计划下的奖励。一般而言,如果股票期权和股票增值权的每股行使价至少等于授予期权或股票增值权时基础股票的每股公允市场价值,则股票期权和股票增值权不受第409A条的约束。限制性股票奖励一般不受第409A条的约束。受限制股份单位须受第409A条规限,除非在(1)发生归属的公司财政年度结束或(2)发生归属的日历年度结束后的两个半月内结算。如果某一授标受第409A条的约束,而行使或结算该授标的规定不符合第409A条的规定,则参与人将被要求在授予部分授标时确认普通收入(无论是否已行使或结算)。这一数额还需缴纳20%的美国联邦税和保费利息,此外还需按照参与者通常的普通收入边际税率缴纳美国联邦所得税。
173
新的计划福利
以前没有根据激励计划授予任何奖励,也没有根据股东对激励计划的批准授予任何奖励。授予任何参与者或参与者群体的奖励在本委托书/招股说明书发布之日无法确定,因为参与和根据激励计划可能授予的奖励类型由计划管理人酌情决定。因此,本代理说明/说明书中没有列入新的计划效益表。
批准须经表决
激励计划提案的批准需要ACIC普通股的多数股份亲自或通过代理人代表并有权投票,在转换后的基础上作为单一类别一起投票。
激励计划提案的条件是每一项必要提案都获得批准。因此,如果所需提议未获批准,即使ACIC的股东批准,激励计划提议也不会产生任何效果。
委员会的建议
ACIC董事会建议ACIC股东投票“赞成”奖励计划提案。
174
Proposal 11:The Director Election Proposal
合并完成后,合并后的公司董事会将由七名董事组成。七名被提名董事的选举取决于业务合并的结束。
被提名人
合并后的公司董事会将由七名董事组成,其中大多数董事将是独立董事,包括GIO在交易结束前指定的五名董事,其中至少三名董事将符合独立董事的资格,两名董事将符合独立董事的资格,另一名董事将由GIO和ACIC各自商定,批准将不会被无理拒绝或延迟,所有这些董事都必须符合独立董事的资格,交易结束后生效,在合并后公司董事会任职,直至合并后公司的年度会议,或该等董事的继任人已被正式选出并符合资格,或该等董事较早前去世、辞职、退休或因故被免职。ACIC提议股东批准在合并完成后选举七名被提名的董事担任合并后的公司董事会成员。董事选举提案正提交ACIC股东审议和表决。
有关每一位被提名董事的经历的更多信息,请参阅本委托书/招股说明书中题为“合并后公司的管理层”的部分。
批准须经表决
核准董事选举提案需要出席特别会议或由代表出席特别会议的ACIC普通股股东的多数票。“多元化”指的是,获得“赞成”票数最多的个人当选为董事。
如果业务合并建议未获批准,董事选举建议将不会在特别会议上提出。
委员会的建议
ACIC董事会建议ACIC股东投票“赞成”董事选举提案的批准,并“赞成”选举本委托书/招股说明书中提名的每一位候选人。
175
提案12:休会提案
休会提案如果获得批准,将允许行政协调会理事会将特别会议延期至以后的日期。在任何情况下,行政协调会都不会将特别会议的休会或完成业务合并的时间超过它根据现行宪章和DGCL可以适当这样做的日期。临时提案的目的是在必要和适当的情况下,提供更多的时间来完善业务合并。
除在核准休会提案后暂停特别会议外,根据特拉华州法律,董事会有权在会议开始前的任何时间推迟特别会议。在这种情况下,ACIC将发布一份新闻稿,并采取它认为在这种情况下必要和实际可行的其他步骤,将延期通知其股东。
延期提议未获核准的后果
如果在特别会议上提出了休会提案,但没有得到ACIC股东的批准,ACIC董事会将不能在没有足够票数支持或与批准企业合并提案或任何其他提案有关的情况下将特别会议推迟到以后的日期。
需要投票
临时提案的核准需要在特别会议上获得亲自或由代理人代表并有权投票的ACIC普通股的多数股份的赞成票。在特别会议上提出休会提案不以核准任何其他提案为条件。
通过暂停提案不以通过任何其他提案为条件。
委员会的建议
ACIC董事会建议ACIC股东投票赞成休会提案。
176
未经审计的合并财务报表
导言
以下未经审计的合并财务信息简明合并报表显示了ACIC和GIO的合并财务信息,并根据业务合并进行了调整。以下未经审计的简明合并财务信息是根据经最终规则第33-10786号“对被收购和处置企业的财务披露的修订”修订的S-X条例第11条编制的。根据美国公认会计原则(“GAAP”),该业务合并将作为反向合并入账。在这种会计方法下,ACIC将被视为财务报告目的的“被收购”公司,而GIO将是会计“收购方”。因此,业务合并将被视为相当于GIO为ACIC的净资产发行股票,同时进行资本重组。ACIC的净资产将按历史成本列报,不记录商誉或其他无形资产。
以下截至2022年12月31日的未经审计的备考简明合并资产负债表将GIO截至2022年12月31日的历史经审计资产负债表与ACIC截至2022年12月31日的历史经审计资产负债表合并,使业务合并的备考效果如同发生在2022年12月31日一样。
以下未经审计的2022年12月31日终了年度合并业务报表合并了GIO截至2022年12月31日终了年度的历史审计业务报表和ACIC截至2022年12月31日终了年度的历史审计业务报表,按形式合并,如同业务合并发生在2022年1月1日。
截至2022年12月31日的未经审计的备考简明合并资产负债表来自:
2022年12月31日终了年度未经审计的合并业务报表简明合并报表来自:
以下未经审计的简明合并财务资料是根据在本委托书/招股说明书之日生效的条例S-X第11条编制的,其中纳入了使用某些假设的财务结果(“交易会计调整”)。在业务合并之前,GIO和ACIC没有任何历史关系。因此,不需要为消除两家公司之间的活动而进行形式上的调整,而且未经审计的形式上精简的合并财务信息没有反映任何预期协同增效、业务效率、节税或节省费用的调整。
177
这些信息应与本委托书/招股说明书中GIO和ACIC各自的财务报表和相关附注(如适用)以及GIO和ACIC的“管理层对财务状况和经营成果的讨论和分析”以及本委托书/招股说明书其他部分的其他财务信息一并阅读。未经审计的形式上的调整是管理层根据截至本代理声明/招股说明书之日所掌握的信息作出的估计,随着获得更多信息和进行分析,可能会有所变动。
交易情况说明
2023年3月8日,ACIC与GIO、买方代表、卖方代表和某些GIO股东签订了业务合并协议。业务合并协议的条款除其他外规定:
| ● | 根据《业务合并协议》的条款,ACIC在交割时向卖方交付的总对价交换考虑")将是ACIC A类普通股的一些新发行股票,总价值为2.50亿美元乘以百分比,等于(i)购买的股票总数除以(ii)GIO已发行和未发行的普通股总数加上GIO的库存股本。GIO在交割后立即以库存形式持有的任何股本将由GIO注销。卖方目前是企业合并协议的一方,合计持有GIO已发行和未发行普通股的98.703%;其他GIO股东可在交易结束前通过在登记声明生效后签署合并协议成为企业合并协议的一方。 |
| ● | 除可于收市时交付的交易所代价外,在收市后的五年期间内盈利期“)某些卖方(”盈利卖家")可能有权获得ACIC A类普通股的额外股份,最大总数等于54,000,000股乘以所购股份百分比的乘积(盈利股份),如果ACIC A类普通股在盈利期间的主要证券交易所的收盘后交易价格达到或超过某些目标价格,或在盈利期间发生某些控制权变更交易,如下所示: |
| (一) | 如在盈利期内任何连续三十个交易日内的任何二十个交易日内,成交量加权平均交易价格交易价格")ACIC A类普通股的股份大于或等于12.50美元,盈利卖方将有权获得总计等于15,000,000乘以所购股份百分比的盈利股份数量; |
| (二) | 如果在盈利期间的任何连续三十个交易日内的任何二十个交易日内,交易价格大于或等于15.00美元,盈利卖方将有权获得总计等于18,000,000乘以所购股份百分比的盈利股份数量;和 |
| (三) | 如果在盈利期间的任何连续三十个交易日内的任何二十个交易日内,交易价格大于或等于17.50美元,盈利卖方将有权获得总计等于21,000,000股与所购股份百分比的乘积的盈利股票数量。 |
如果在盈利期内,合并后公司的控制权发生变更,据此合并后公司或其股东有权收取对价,该对价意味着A类普通股的每股价值等于或超过一个或多个触发事件所依据的交易价格,那么,在此控制权变更完成之前,(i)在相关触发事件以前未曾发生的范围内,此类相关触发事件应被视为已经发生,并且(ii)每个盈余卖方应有权根据被视为发生的适用触发事件获得其所发行的适用盈余股票数量的按比例份额。
有关企业合并和与之相关的某些协议的描述,请参阅“代理声明/说明书摘要——企业合并”和“与企业合并相关的某些协议”。
178
企业合并会计
根据美国公认会计原则,该业务合并将作为反向合并入账。在这种会计方法下,出于财务报告目的,ACIC将被视为“被收购”公司,而GIO将成为会计“收购方”。这一决定主要基于以下假设:
179
另一个决定性因素是,ACIC不符合ASC 805-10-55对“企业”的定义,因此,出于会计目的,根据美国公认会计原则,企业合并将作为反向合并进行会计处理。ACIC的净资产将按历史成本列报,不记录商誉或其他无形资产。向ACIC发行的股票的公允价值超过所取得的ACIC可辨认净资产的公允价值的部分,即为其股票在证券交易所上市的补偿,并在发生时计入费用。
备考列报的基础
ACIC已选择将ACIC公众股份在两种不同赎回情形下的未经审计的合并财务信息提供为现金,详情如下:
在备考合并财务报表中列出的已发行股份和加权平均已发行股份中,包括根据业务合并协议的条款在收盘时向GIO卖方发行的总计23,568,155股ACIC A类普通股。盈利股份未包括在内,因为这些股份被视为在发生或有盈利拨备时发行的金融工具。盈利股票将在ASC主题815-40“衍生工具和套期保值”下入账,据此,盈利股票被视为与公司股票挂钩,因此将被归类为权益工具。
180
下表列出了假设“无赎回情形”和“BCA最大赎回情形”的形式上GIO的股份所有权:
没有赎回 |
BCA最大值 |
||||||||
形式所有权 |
|
编号 |
|
百分比 |
|
编号 |
|
百分比 |
|
GIO卖家 |
23,568,155 |
80.3 |
% |
23,568,155 |
81.1 |
% |
|||
ACIC公众股东 |
1,502,203 |
5.1 |
% |
1,175,322 |
4.1 |
% |
|||
赞助商 |
4,312,500 |
14.6 |
% |
4,312,500 |
14.8 |
% |
|||
已发行股份总数 |
29,382,858 |
29,055,977 |
|||||||
以下截至2022年12月31日的未经审计的备考简明合并资产负债表和截至2022年12月31日止年度的未经审计备考简明合并经营报表基于ACIC和GIO的历史财务报表。未经审计的形式调整是根据目前可获得的资料、假设和形式调整所依据的估计数作出的,并在所附的说明中加以说明。实际结果可能与列报所附未经审计的简明合并财务报表所用的假设存在重大差异。
181
未经审计的备考简明合并资产负债表
截至2022年12月31日(1)
方案1:无赎回方案 |
场景2:BCA最大赎回场景 |
|||||||||||||||||
GIO |
ACIC |
交易 |
交易 |
|||||||||||||||
(美国公认会计原则 |
(美国公认会计原则 |
会计 |
备考 |
会计 |
备考 |
|||||||||||||
|
历史) |
|
历史) |
|
调整 |
|
合并 |
|
调整 |
|
合并 |
|||||||
物业、厂房及设备 |
||||||||||||||||||
流动资产 |
||||||||||||||||||
现金及现金等价物 |
$ |
17,791 |
$ |
1,094,384 |
$ |
15,731,024 |
B |
$ |
3,423,084 |
$ |
(3,423,084) |
G |
$ |
— |
||||
(9,075,000) |
C |
— |
||||||||||||||||
(4,097,252) |
D |
— |
||||||||||||||||
(247,863) |
I |
|||||||||||||||||
250,000 |
K |
|||||||||||||||||
(250,000) |
L |
|||||||||||||||||
预付费用和其他资产 |
11,909 |
177,083 |
900,000 |
D |
1,088,992 |
— |
1,088,992 |
|||||||||||
流动资产总额 |
29,701 |
1,271,467 |
3,210,909 |
4,512,077 |
(3,423,084) |
1,088,992 |
||||||||||||
非流动资产 |
||||||||||||||||||
信托账户中持有的现金和有价证券 |
— |
16,182,549 |
(716,610) |
A |
— |
— |
— |
|||||||||||
(15,731,024) |
B |
|||||||||||||||||
247,863 |
I |
|||||||||||||||||
17,222 |
J |
|||||||||||||||||
非流动资产合计 |
— |
16,182,549 |
(16,182,549) |
— |
— |
— |
||||||||||||
总资产 |
$ |
29,701 |
$ |
17,454,016 |
$ |
(12,971,640) |
$ |
4,512,077 |
$ |
(3,423,084) |
$ |
1,088,992 |
||||||
负债 |
||||||||||||||||||
流动负债 |
||||||||||||||||||
应付账款和应计费用 |
— |
830,785 |
(263,130) |
D |
567,655 |
— |
567,655 |
|||||||||||
应付本票-关联方 |
— |
— |
250,000 |
K |
— |
— |
— |
|||||||||||
(250,000) |
L |
|||||||||||||||||
应交所得税 |
— |
588,493 |
(133,962) |
J |
454,531 |
— |
454,531 |
|||||||||||
强制性可赎回普通股负债 |
716,610 |
(716,610) |
A |
— |
— |
|||||||||||||
流动负债合计 |
— |
2,135,888 |
(1,113,702) |
1,022,186 |
— |
1,022,186 |
||||||||||||
非流动负债 |
||||||||||||||||||
递延承销佣金 |
— |
9,075,000 |
(9,075,000) |
C |
— |
— |
— |
|||||||||||
认股权证负债 |
— |
2,523,750 |
— |
2,523,750 |
— |
2,523,750 |
||||||||||||
非流动负债合计 |
— |
11,598,750 |
(9,075,000) |
2,523,750 |
— |
2,523,750 |
||||||||||||
负债总额 |
— |
13,734,638 |
(10,188,702) |
3,545,936 |
— |
3,545,936 |
||||||||||||
可能赎回的A类普通股 |
— |
15,381,820 |
(15,381,820) |
G |
— |
— |
— |
|||||||||||
股权 |
||||||||||||||||||
GIO普通股 |
2,420 |
— |
(2,420) |
E |
— |
— |
— |
|||||||||||
Apeiron优先股 |
— |
— |
— |
— |
— |
|||||||||||||
Apeiron A类普通股 |
— |
— |
2,357 |
E |
2,938 |
(32) |
G |
2,906 |
||||||||||
150 |
G |
|||||||||||||||||
431 |
H |
|||||||||||||||||
Apeiron B类普通股 |
— |
431 |
(431) |
H |
— |
— |
— |
|||||||||||
额外实收资本 |
264,964 |
— |
(1,700,000) |
D |
1,049,702 |
(3,423,052) |
G |
(2,373,350) |
||||||||||
63 |
E |
— |
||||||||||||||||
(12,896,995) |
F |
|||||||||||||||||
15,381,670 |
G |
|||||||||||||||||
累计赤字 |
(237,672) |
(11,662,873) |
(1,234,122) |
D |
(86,488) |
— |
(86,488) |
|||||||||||
12,896,995 |
F |
|||||||||||||||||
151,184 |
J |
|||||||||||||||||
外汇损益 |
(11) |
(11) |
(11) |
|||||||||||||||
总股本 |
29,701 |
(11,662,442) |
12,598,882 |
966,141 |
(3,423,084) |
(2,456,943) |
||||||||||||
总权益和负债 |
$ |
29,701 |
$ |
17,454,016 |
$ |
(12,971,640) |
$ |
4,512,077 |
$ |
(3,423,084) |
$ |
1,088,993 |
||||||
(1)截至2022年12月31日止年度未经审计的备考简明合并经营报表将GIO截至2022年12月31日止年度的历史经审计经营报表与ACIC截至2022年12月31日止年度的历史经审计经营报表合并。
182
未经审计的合并业务报表
截至2022年12月31日止年度(2)
|
|
|
方案1:无赎回方案 |
|
场景2:BCA最大赎回场景 |
|
|||||||||||||
GIO |
ACIC |
交易 |
交易 |
||||||||||||||||
(美国公认会计原则 |
(美国公认会计原则 |
会计 |
备考 |
会计 |
备考 |
||||||||||||||
历史) |
历史) |
调整 |
合并 |
调整 |
合并 |
||||||||||||||
销售收入 |
$ |
— |
$ |
— |
$ |
— |
$ |
— |
$ |
— |
$ |
— |
|||||||
销售成本 |
|
— |
|
— |
|
— |
|
— |
|
— |
|
— |
|||||||
毛利 |
|
— |
|
— |
|
— |
|
— |
|
— |
|
— |
|||||||
|
|||||||||||||||||||
专业费用 |
|
(121,071) |
|
— |
|
— |
|
(121,071) |
|
— |
(121,071) |
||||||||
组建和业务费用 |
— |
(1,203,615) |
|
— |
|
(1,203,615) |
— |
(1,203,615) |
|||||||||||
广告和营销 |
|
(95,265) |
|
— |
|
— |
|
(95,265) |
|
— |
|
(95,265) |
|||||||
差旅费 |
|
(12,905) |
|
— |
|
— |
|
(12,905) |
|
— |
|
(12,905) |
|||||||
一般和行政费用 |
|
(12,855) |
|
— |
|
(150,000) |
CC |
|
(162,855) |
|
— |
|
(162,855) |
|
|||||
交易成本 |
|
— |
|
— |
|
(1,234,122) |
BB |
|
(1,234,122) |
|
— |
|
(1,234,122) |
|
|||||
认股权证公允价值变动 |
|
— |
|
6,057,000 |
|
— |
|
6,057,000 |
|
— |
|
6,057,000 |
|||||||
信托账户持有的有价证券所赚取的利息 |
|
— |
|
2,318,006 |
|
(2,318,006) |
AA |
|
— |
|
— |
|
— |
|
|||||
所得税前利润(亏损) |
|
(242,096) |
|
7,171,391 |
|
(3,702,128) |
|
3,227,167 |
|
— |
|
3,227,167 |
|
||||||
所得税费用 |
|
— |
|
(588,493) |
|
— |
|
(588,493) |
|
— |
|
(588,493) |
|
||||||
净收入(亏损) |
$ |
(242,096) |
$ |
6,582,898 |
$ |
(3,702,128) |
$ |
2,638,674 |
$ |
— |
$ |
2,638,674 |
|
||||||
$ |
— |
|
|
|
|
|
|
|
|
|
|
|
|||||||
每股基本和摊薄净亏损,可赎回A类普通股 |
$ |
0.31 |
|
|
|
|
|
|
|
|
|
||||||||
B类普通股每股基本和摊薄净亏损 |
$ |
0.31 |
|
|
|
|
|
|
|
|
|
||||||||
已发行股票的预计加权平均数-基本和稀释 |
|
|
|
|
29,382,858 |
(1) |
|
|
|
29,055,977 |
(1) |
||||||||
预计每股收益----基本和稀释 |
|
|
$ |
0.09 |
|
|
$ |
0.09 |
|
||||||||||
(1) |
详见附注7 ——“每股净收益(亏损)”。 |
(2) |
2022年12月31日终了年度未经审计的合并业务报表合并了GIO截至2022年12月31日终了年度的历史审计业务报表和ACIC截至2022年12月31日终了年度的历史审计业务报表。 |
183
未经审计的合并财务报表附注
附注1 ——交易情况说明
2023年3月8日,ACIC与GIO、Apeiron Capital保荐人有限责任公司(GIO的买方代表)、GIO的股东(在交易登记声明生效后但在交易结束前通过签署合并协议而成为企业合并协议一方的“签署卖方”,即“卖方”)和Deven Patel(就企业合并协议的某些部分而言)以卖方代表的身份签订了《企业合并协议》(“卖方代表”)。企业合并协议所设想的交易,包括ACIC证券的发行,被称为“企业合并”或“交易”。
交换考虑
根据业务合并协议的条款,ACIC在交割时向卖方交付的总对价(“交换对价”)将是ACIC新发行的A类普通股的数量,总价值为2.50亿美元乘以百分比,等于(i)购买的股份总数除以(ii)GIO已发行和未发行的普通股总数加上GIO库存中持有的股本股份数量。GIO在交割后立即以库存形式持有的任何股本将由GIO注销。卖方目前是企业合并协议的一方,合计持有GIO已发行和流通普通股的98.703%;额外的GIO股东可在交割前通过在登记声明生效后签署合并协议成为企业合并协议的一方。
除了在收盘时可交付的对价外,在收盘后,某些卖方(“盈利卖方”)可能有权获得额外的ACIC A类普通股股份,金额不超过54,000,000股乘以所购股份百分比(“盈利股份”),如果在从生效时间开始到截止日期五周年结束的期间(“盈利期间”)满足某些指标。具体来说:
| (一) | 如果在盈利期内的任何连续三十个交易日内的任何二十个交易日内,ACIC A类普通股的股票交易价格大于或等于12.50美元,盈利期卖方将有权获得总计等于15,000,000乘以所购股票百分比的盈利期股票数量; |
| (二) | 如果在盈利期间的任何连续三十个交易日内的任何二十个交易日内,交易价格大于或等于15.00美元,盈利卖方将有权获得总计等于18,000,000乘以所购股份百分比的盈利股份数量;和 |
| (三) | 如果在盈利期间的任何连续三十个交易日内的任何二十个交易日内,交易价格大于或等于17.50美元,盈利卖方将有权获得总计等于21,000,000股与所购股份百分比的乘积的盈利股票数量。 |
如果在盈利期内,合并后公司的控制权发生变更,据此合并后公司或其股东有权收取对价,该对价意味着A类普通股的每股价值等于或超过一个或多个触发事件所依据的交易价格,那么,在此控制权变更完成之前,(i)在相关触发事件以前未曾发生的范围内,此类相关触发事件应被视为已经发生,并且(ii)每个盈余卖方应有权根据被视为发生的适用触发事件获得其所发行的适用盈余股票数量的按比例份额。
有关企业合并和与之相关的某些协议的描述,请参阅“代理声明/说明书摘要——企业合并”和“与企业合并相关的某些协议”。
附注2 ——列报和会计政策的基础
未经审计的简明合并财务资料仅供说明之用。如果两家公司总是合并在一起,财务结果可能会有所不同。你不应依赖未经审计的合并财务资料,把未经审计的合并财务资料当作历史业绩的指示物,如果这些公司一直是
184
以下未经审计的简明合并财务信息是根据经最终规则第33-10786号“对被收购和处置企业的财务披露的修订”修订的S-X条例第11条编制的。第33-10786号发布用简化的交易会计调整取代了现有的形式调整标准,并提出了管理层的调整。ACIC选择不提交管理层的调整,只在以下未经审计的简明合并财务信息中提交交易会计调整。
根据ASC 805-10-55,ACIC不符合“企业”的定义,因为它是一个空壳上市公司,只持有作为其原始股票发行的一部分筹集的现金。因此,企业合并不符合ASC 805所指的“企业合并”;相反,根据美国公认会计原则,企业合并将被视为反向合并。详见附注3 ——企业合并会计。
GIO的历史财务报表是按照美国公认会计原则编制的,其功能和列报货币为英镑(“GBP”)。ACIC的历史财务报表是按照美国公认会计原则编制的,其功能和列报货币为美元(“USD”)。未经审计的简明合并财务信息反映了美国公认会计原则,即GIO使用的会计基础。
为在未经审计的简明合并财务资料中列报,GIO的历史财务报表已换算成美元,并以美元列报,采用以下汇率:
| ● | 按资产负债表截至2022年12月31日的期末汇率1.2098计算。 |
| ● | 截至2022年1月1日至2022年12月31日期间业务报表的平均汇率1.2369。 |
ACIC已选择将ACIC公众股份在两种不同赎回情形下的未经审计的合并财务信息提供为现金,详情如下:
| ● | 假设没有赎回:本演示文稿假定ACIC的任何公众股东都不对其公众股份行使赎回权。 |
| ● | 假设BCA最大赎回:这一列报假定:(一)326881股公众股赎回,赎回付款总额为340万美元,假定根据截至2023年4月30日信托账户的资金计算的每股赎回价格为10.47美元;(二)如果ACIC在收盘时没有现金或现金等价物,拟议的业务合并将不会完成,包括信托账户中的剩余资金(在完成和支付赎回款项后)和任何交易融资的收益,至少相当于在交易结束时支付ACIC和GIO的估计交易费用和负债所需的数额费用条件,”如下文进一步描述)。由于ACIC的所有Insiders在ACIC IPO时都放弃了赎回权,本演示文稿中只反映了公众股东的赎回。这一设想方案包括“无赎回”设想方案中所载的所有调整,并提出额外的调整,以反映《巴塞尔公约》最大赎回的影响,同时考虑到费用条件。“BCA最大赎回情形”(i)假设NTA提案在特别会议上获得ACIC股东的批准,并且(ii)代表在满足费用条件的情况下可赎回的最大公众股份数量;但是,前提是根据业务合并协议的条款,费用条件不是完成交易的合同条件,并且业务合并可以在不满足费用条件的情况下按照合同交易条款完成。如果企业合并在费用条件未得到满足的情况下完成(或者,如果估计的交易费用或任何交易融资的收益(如果有的话)导致在截止日期的费用条件与本BCA最大赎回情景演示文稿中包含的假设不同),最多可赎回“BCA最大赎回情景”中所反映的1175322股公众股票。 |
186
下表列出了合并后公司在交易结束后的形式上的股份所有权,假设分别为“无赎回情形”和“BCA最大赎回情形”:
没有赎回 |
BCA最大值 |
||||||||
业务合并后的所有权百分比 |
|
编号 |
|
百分比 |
|
编号 |
|
百分比 |
|
GIO卖家 |
23,568,155 |
80.3 |
% |
23,568,155 |
81.1 |
% |
|||
ACIC公众股东 |
1,502,203 |
5.1 |
% |
1,175,322 |
4.1 |
% |
|||
赞助商 |
4,312,500 |
14.6 |
% |
4,312,500 |
14.8 |
% |
|||
已发行股份总数 |
29,382,858 |
29,055,977 |
|||||||
这种形式上的调整不会产生所得税影响,因为它们要么是(一)不需缴纳公司所得税的法律实体发生的,要么是(二)根据有关法域的法律永久不能扣除或不应纳税的。
上述股份数额和所有权百分比并不表示投票百分比,也没有考虑到在企业合并后仍未兑现并可在其后行使的ACIC认股权证。
业务合并完成后,管理层将对两个实体的会计政策进行全面审查。作为审查的结果,管理层可能会发现两个实体的会计政策之间的差异,这些差异如果得到遵守,可能会对合并后公司的财务报表产生重大影响。管理层没有发现任何会对未经审计的简明合并财务信息产生重大影响的差异。因此,未经审计的备考简明合并财务信息不假定会计政策有任何差异。
附注3 ——企业合并的会计处理
根据美国公认会计原则,该业务合并将作为反向合并入账。在这种会计方法下,ACIC将被视为财务报告目的的“被收购”公司,而GIO将是会计“收购方”。这一决定主要基于以下假设:
| ● | GIO目前的股东将持有ACIC post Business Combination的多数投票权; |
| ● | 合并后的董事会将由7名董事组成,其中包括GIO指定的5名董事和ACIC指定的2名董事; |
| ● | GIO的业务将主要包括ACIC的持续业务;以及 |
| ● | GIO的高级管理层将由ACIC的高级管理层组成。 |
另一个决定性因素是,ACIC不符合ASC 805-10-55对“企业”的定义,因此,为会计目的,企业合并将作为ASC 805范围内的反向合并进行会计处理。ACIC的净资产将按历史成本列报,不记录商誉或其他无形资产。向ACIC发行的股票的公允价值超过所取得的ACIC可辨认净资产的公允价值的部分,即为其股票在证券交易所上市的补偿,并在发生时计入费用。
附注4 ——截至2022年12月31日对未经审计的备考合并资产负债表的调整
截至2022年12月31日未经审计的简明合并资产负债表的备考调整如下:
a. |
反映支付强制性可赎回股票负债70万美元。 |
b. |
反映将信托账户中的1570万美元资金清理和重新分类为业务合并后可用的现金。 |
187
c. |
反映业务合并结束时递延承销佣金的减少和结算。 |
d. |
系预计ACIC和GIO为业务合并所产生的法律、会计和尽职调查费用约430万美元的初步估计交易费用。对于220万美元的ACIC交易费用,30万美元已作为预计资产负债表日期的一部分应计,其中10万美元已支付,60万美元将记为预付董事和高级职员(“D & O”)保险费。其余120万美元反映为对累计赤字的调整。对于210万美元的GIO交易费用,截至预计资产负债表日已支付其中的10万美元,30万美元将记为预付的D & O保险费。其余170万美元反映为对额外实收资本的调整。 |
e. |
系指在企业合并后,卖方持有的GIO股份以每股面值0.0001美元兑换为ACIC A类普通股23568155股。 |
f. |
表示上文(D)所述在记录ACIC将产生的交易费用后,ACIC的历史累计损失的冲销。 |
g. |
在情形1中,反映了无赎回情形。在设想方案2中,反映了BCA最大赎回326881股ACIC普通股,用于支付340万美元的总赎回款项,赎回价格约为每股赎回价格10.47美元,该设想方案表示在满足费用条件的情况下可赎回的公众股份的最大数量;但条件是,根据业务合并协议的条款,费用条件不是完成交易的合同条件,并且业务合并可在不满足费用条件的情况下根据业务合并协议的条款完成。企业合并协议规定,除非ACIC股东批准招股说明书/代理声明中所载的NTA提案,并且修改现行章程以取消净资产测试条件,否则完成企业合并的条件是ACIC在实施股票赎回和支付SPAC交易费用后拥有至少500万美元的有形净资产。BCA最大赎回方案假设NTA提案获得批准,该提案取消了限制ACIC拥有低于5,000,001美元净有形资产能力的现行章程要求,并且ACIC拥有满足支出条件所需的现金和现金等价物。 |
h. |
反映ACIC B类普通股在一对一的基础上转换为A类普通股的情况。 |
i. |
反映2023年2月、3月和4月向信托账户支付的延期付款。 |
j. |
反映2022年12月31日之后信托账户赚取的利息和从信托账户提取的用于支付ACIC某些纳税义务的利息。 |
k. |
反映2022年12月31日之后签发的本票,用于向信托账户支付延期付款。 |
l. |
反映赞助商贷款的偿还情况。 |
附注5 ——对截至2022年12月31日止年度未经审计的备考简明合并业务报表的调整和重新分类
2022年12月31日终了年度未经审计的简明合并业务报表所列的预计调整如下:
AA。 |
反映业务合并生效后信托账户所持投资产生的利息收入的注销情况,如同发生在2022年1月1日一样。 |
BB。 |
系一项调整,其中包括上文调整(D)中所列的预估资产负债表调整的影响,总额为120万美元,用于预计由行政协调会承担的业务合并的直接增量费用,假定这些调整是在所列财政年度开始时作出的。由于这些费用与业务合并直接相关,预计在业务合并后12个月后,合并后公司的收入中不会再出现这些费用。 |
188
CC。 |
反映D & O保单的摊销。 |
附注6 ——每股净收益
表示使用历史加权平均已发行股份和与业务合并有关的额外发行股份计算的每股收益,假设这些股份自2022年1月1日起未发行。由于业务合并的反映就好像是在所列期间开始时发生的一样,计算基本和稀释每股收益的加权平均未发行股票时假定,与业务合并有关的已发行股票在所列期间的整个期间都未发行。如果上述“假设BCA最大赎回”情景下描述的公众股份数量被赎回,则此计算将被追溯调整,以消除整个期间的此类股份。
未经审计的简明合并财务信息是在假设ACIC公众股份的两种不同赎回水平的情况下编制的:
对于 |
||||||
|
假设没有 |
|
假设 |
|||
加权平均已发行股份----基本和稀释 |
||||||
GIO卖家 |
23,568,155 |
23,568,155 |
||||
ACIC公众股东 |
1,502,203 |
1,175,322 |
||||
赞助商 |
4,312,500 |
4,312,500 |
||||
合计 |
29,382,858 |
29,055,977 |
||||
年终 |
||||||
|
假设没有 |
|
假设 |
|||
预计净收入 |
$ |
2,638,674 |
$ |
2,638,674 |
||
已发行普通股加权平均股----基本和稀释 |
29,382,858 |
29,055,977 |
||||
每股净收益----基本和稀释 |
$ |
0.09 |
$ |
0.09 |
||
不包括的证券:(1) |
||||||
公开认股权证 |
8,625,000 |
8,625,000 |
||||
私募认股权证 |
8,200,000 |
8,200,000 |
||||
| (1) | 在计算每股基本和稀释的预计净亏损时,将可能具有稀释性的未偿付证券排除在外,因为这些证券的影响本来是反稀释的。 |
189
关于ACIC的信息
导言
ACIC是一家空白支票公司,于2020年12月28日根据特拉华州法律成立,目的是与一个或多个企业或实体进行合并、股份交换、资产收购、股票购买、资本重组、重组或其他类似的业务合并。ACIC迄今未产生任何营业收入,在完成初步业务合并之前不会产生营业收入。
自成立以来的重要活动
2021年11月12日,ACIC完成了17,250,000股的IPO,其中2,250,000股是根据承销商行使超额配股权而发行的。每个单位包括一股公开股票和一份公开认股权证的一半,每份完整认股权证的持有者有权以每股11.50美元的价格购买一股普通股。ACIC单位以每单位10.00美元的价格出售,总收益为172500000美元。
2021年11月12日,在完成首次公开发行的同时,公司完成了向保荐人和代表非公开出售8,200,000份认股权证(“配售认股权证”)(向保荐人出售7,450,000份配售认股权证,向代表出售750,000份配售认股权证),购买价格为每份配售认股权证1.00美元,总收益为8,200,000美元。
共计175950000美元,包括167750000美元的首次公开发行收益和8200000美元的非公开发行收益,存入大陆集团作为受托人在美国设立的一个信托账户。
2022年12月21日,ACIC召开了一次股东特别会议,会上提议修改ACIC经修订和重述的公司注册证书,将ACIC完成初始业务合并的日期从2023年2月12日延长至2023年8月14日。就本次延期而言,保荐人同意向美国提供以下贷款:(i)(x)总额为125,000美元或(y)未赎回的每一股公开股份的0.05美元(该金额,“每月金额”)中的较低者,加上(ii)如果企业合并未能在2023年3月12日之前完成,则为每个日历月(从2023年3月13日开始,到随后每个月的第12天结束)的每月金额,或公司在2023年8月14日之前完成企业合并所需的部分金额。因此,每股存入的金额将取决于与延期有关的赎回后仍未发行的公众股份的数量以及完成业务合并所需的延期期限的长短。截至2023年5月5日,赞助人已将共计330484.68美元的贷款存入信托账户。
ACIC于2023年1月31日收到纽约证交所员工的书面通知,称ACIC没有遵守《纽约证交所上市公司手册》第802.01B节的规定,该节要求上市公司在连续30个交易日内保持其公开持股的全球平均总市值至少为40,000,000美元。纽约证券交易所还告知公司,由于未能遵守《市值要求》,纽约证券交易所决定启动程序,从纽约证券交易所摘牌公司的A类普通股、购买A类普通股的认股权证和单位,每个单位包括一股A类普通股和一份可赎回认股权证的二分之一(统称“公司证券”)。
2023年1月31日,纽约证券交易所发布新闻稿称,将摘牌该公司的证券,这些证券被立即暂停交易,自那时以来一直没有在纽约证券交易所交易。2023年2月15日,纽约证交所向美国证交会提交了一份表格25,以完成退市。除名在提交表格25十天后生效。ACIC的证券继续在OTCM交易,股票代码分别为“APNCU”、“APNC”和“APNCW”。
股东对企业合并的批准
ACIC正寻求股东在特别会议上批准企业合并,就该会议而言,公众股东可按照本委托书/招股说明书中所述的程序将其公众股份赎回为现金。
拥有ACIC已发行和流通普通股74.2%股份的保荐人,此前已同意将其所有普通股投票支持提交给他们审批的企业合并,包括企业合并。此外,内部人士及其关联公司已同意对他们拥有的任何普通股进行投票,以支持企业合并。
190
根据现行章程,如果ACIC在企业合并完成之前或完成时不拥有至少5000,001美元的有形净资产,考虑到公众股东适当要求赎回的所有公众股份的现金赎回,ACIC将不赎回任何公众股份。
赎回权
就特别会议而言,公众股东(但不包括ACIC的内部人士)可寻求对其公众股份行使赎回权,无论他们是否投票赞成或反对企业合并,以换取赎回价格。尽管如此,ACIC的内部人士已同意,根据与我们的内部人士信函,不行使他们的权利,赎回他们所持有的任何公众股份。公众股东的赎回权,如果按照本委托书/招股说明书中所述的方式适当行使,将根据现行章程和DGCL生效。在特别会议上,公众股东有权投票支持或反对企业合并,但仍可要求赎回其公众股份。
ACIC的“内部人”将不会对他们直接或间接拥有的任何普通股拥有赎回权,无论是在IPO之前购买的,还是在IPO或售后市场购买的。此外,保荐人和Cantor对其拥有的任何私人认股权证不享有赎回权。
根据ACIC的现行章程,如果企业合并完成,公众股东可以要求ACIC将其全部或部分公众股份赎回为现金,但有某些限制,以换取与适用的赎回价格相等的现金;但是,如果此类赎回将导致ACIC在企业合并完成之前或之后不拥有至少为5,000,001美元的净有形资产(根据《交易法》确定),则ACIC不得赎回此类股份。
只有在以下情况下,公众股东才有权获得赎回任何公众股份的现金:
| (a) | 持有公众股份或通过ACIC单位持有公众股份,并在行使公众股份的赎回权之前选择将这些ACIC单位分离为基础公众股份和认股权证;和 |
| (b) | 美国东部时间下午5时前,在[·]、2023年(特别会议投票前两个工作日)(或ACIC自行决定批准的较后日期),(i)向转让代理提交书面请求,要求ACIC以现金赎回您的公众股份,以及(ii)通过DTC以实物或电子方式将您的股票证书(如有)和其他赎回表格交付给转让代理。 |
ACIC单位的持有人在行使有关公众股份的赎回权之前,必须选择将基础公众股份和认股权证分开。持有人可以指示其银行、经纪人或其他代名人这样做,或者,如果持有人持有以自己的名义注册的ACIC单位,持有人必须直接与转让代理联系并指示其这样做。
公众股东可以选择赎回其全部或部分公众股份,无论他们是否投票赞成或反对企业合并提案。
任何赎回要求一经提出,可随时撤回,直至要求赎回的截止日期,其后经ACIC同意,直至企业合并完成,或ACIC董事会确定的其他日期。
ACIC首席执行官必须在特别会议就业务合并进行表决前两个工作日收到任何更正或更改的赎回权利书面要求。除非持有人的股票(如有的话)及其他赎回表格已于特别会议表决前至少两个营业日(以实物或电子方式)交付转让代理人,否则赎回要求将不会获履行。
寻求行使赎回权并选择交付实物证书和其他赎回形式的公众股东应分配足够的时间从转让代理获得实物证书和交付时间。ACIC的理解是,公众股东通常应至少分配两周时间从转让代理获得实物证书。然而,ACIC对这一过程没有任何控制权,可能需要两周以上的时间。以街道名义持有股份的公众股东必须与其银行、经纪人或其他被提名人协调,以电子方式证明或交付股份。这一招标过程以及通过DWAC系统对股票进行认证或交付的行为,都会产生名义上的成本。转让代理通常会向投标经纪人收取象征性的费用,是否将这笔费用转嫁给赎回股东将取决于经纪人。如果企业合并没有完成,这可能会导致股东返还股份的额外成本。
191
如果公众股东如上文所述正确要求赎回,并且企业合并完成,ACIC将赎回股份。这些款项将在业务合并完成后立即支付。如果您行使您的赎回权,那么您将把您的ACIC普通股股票换成现金,并且在业务合并后将不再拥有这些股票。
如果你是一个公众股东,行使你的赎回权将不会导致你的任何公开认股权证的行使或损失,这些认股权证将继续未付,并在业务合并完成后可行使。
私人认股权证持有人不享有与企业合并有关的赎回权。
如果初始业务合并因任何原因未获批准或完成,那么选择行使赎回权的公众股东将无权行使其权利,以信托账户适用的按比例份额赎回其公众股份。在这种情况下,ACIC将立即退回任何股票(如果有的话)和公众股东交付的其他赎回表格。
赎回权的限制
就企业合并而言,公众股东,连同该股东的任何关联公司或与该股东一致行动的任何其他人,或作为“集团”(根据《交易法》第13条的定义),将被限制要求转换其在IPO中出售的股份总数的15%以上的股份。ACIC认为,上述限制将阻止股东累积大量股份,随后这些股东试图利用其转换股份的能力,迫使我们或ACIC的管理层以高于当时市场价格的显著溢价或其他不受欢迎的条款购买他们的股份。如果没有这一规定,如果我们或ACIC的管理层没有以高于当时市场价格的价格或其他不受欢迎的条款购买该持有人的股份,那么持有IPO中出售的股份总数超过15%的公众股东可能会威胁对初始业务合并行使其转换权。ACIC认为,通过限制ACIC的股东转换不超过15%的首次公开发行股票的能力,这将限制一小群股东不合理地试图阻止ACIC完成初始业务合并的能力,特别是在与Rally的初始业务合并中,ACIC必须拥有最低净值或一定数量的现金作为完成交易的条件,例如业务合并。然而,我们不会限制ACIC的股东投票支持或反对ACIC最初的业务合并的能力。
如无企业合并,则赎回公众股份
如果ACIC不能在2023年8月14日之前完成业务合并,ACIC将(i)停止所有业务,除非是为了清盘,(ii)在合理可能的范围内,但在不超过十个工作日后,以每股价格赎回100%的已发行公众股份,以现金支付,金额相当于当时存入信托账户的总金额,包括信托账户中以前未用于支付ACIC纳税义务的资金所赚取的任何利息,除以当时已发行的公众股份的数量,根据适用的法律,该赎回将彻底取消公众股东作为股东的权利(包括获得进一步清算分配的权利,如果有的话),以及(iii)在赎回后,在得到ACIC其余股东和ACIC董事会批准的情况下,在合理可能的范围内尽快清算和解散,但(在上述(ii)和(iii)的情况下)ACIC根据DGCL规定债权人债权的义务和其他适用法律的要求。
在赎回公众股份之前,ACIC将被要求评估ACIC债权人可能对我们提出的所有债权的实际欠款金额,并为这些金额计提准备金,因为债权人的债权优先于公众股东。不能保证ACIC会适当评估所有可能对其提出的索赔。因此,根据适用的债务人/债权人或破产法或破产法,公共股东收到的任何分配都可被视为一种优先转让或欺诈性优先、转让或处分,破产法院可寻求追回ACIC公共股东收到的所有款项。此外,虽然我们寻求让所有供应商和服务提供商(包括受聘协助我们寻找业务合并目标的第三方)和潜在目标企业执行豁免,但这些方可能不会执行此类协议,或者即使他们执行此类协议,也可能不会阻止他们对信托账户提出索赔,包括但不限于欺诈性诱导、违反信托责任或其他类似索赔,以及质疑豁免的可执行性的索赔,在每一种情况下,都是为了在针对ACIC资产(包括信托账户中的资金)的索赔中获得好处。
192
ACIC的内部人士和Cantor均已同意放弃参与任何清算ACIC信托账户有关创始人股份和私人认股权证的权利。信托账户不会发放到期时一文不值的担保。
如果ACIC不能完成初始业务合并并用掉ACIC首次公开发行的所有净收益,而不是存入信托账户的收益,则信托账户的每股分配约为[·]美元(基于截至2023年[·]的信托账户余额)。
然而,存放在信托账户中的收益可能会先于公共股东的债权,成为ACIC债权人的债权。尽管ACIC将寻求让所有供应商,包括借款的贷款人、潜在的目标企业或我们聘用的其他实体与我们签订协议,放弃对信托账户中为公众股东持有的任何款项的任何权利、所有权、利息或任何类型的索赔,但不能保证他们会执行此类协议,或者即使他们执行此类协议,他们也不会被阻止对信托账户提出索赔,包括但不限于欺诈性诱导、违反信托责任或其他类似索赔,以及对豁免的可执行性提出质疑的索赔,在每一种情况下,都是为了对ACIC的资产(包括信托账户中的资金)提出索赔而获得优势。如果任何第三方拒绝执行一项协议,放弃对信托账户所持款项的这种索偿权,我们将分析如果我们选择不与这种第三方接触,我们可利用的替代办法,并评估如果这种第三方拒绝放弃这种索偿权,这种接触是否符合公共股东的最佳利益。我们可能聘用拒绝执行豁免的第三方的例子包括聘用第三方顾问,管理层认为该第三方顾问的专长或技能明显优于同意执行豁免的其他顾问,或在管理层无法找到愿意提供豁免的所需服务提供者的情况下。无论如何,ACIC的管理层将对其可用的替代方案进行分析,并且只有在管理层认为第三方的参与比任何替代方案对我们都更有利的情况下,才会与不执行豁免的第三方达成协议。此外,不能保证这些实体同意放弃它们将来可能因与我们的任何谈判、合同或协议而产生的任何债权,也不会以任何理由向信托账户寻求追索。
保荐人已同意,如果我们在企业合并完成前清算信托账户,其个人有责任向目标企业或供应商或其他实体支付债务和义务,这些企业或供应商或其他实体因我们提供或签约的服务或向我们出售的产品而欠我们的款项超过信托账户中未持有的IPO净收益,但仅限于确保此类债务或义务不会减少信托账户中的数额所需的范围内,且仅限于此类当事方未执行放弃义务的情况。但是,不能保证如果要求它履行这些义务,它将能够履行这些义务。因此,由于债权人的债权,实际每股分配可能低于[·]美元(基于截至2023年[·]的信托账户余额)。此外,如果我们被迫提交破产案,或者对我们提出非自愿破产案但未被驳回,信托账户中持有的收益可能会受到适用的破产法的约束,并可能被纳入ACIC的破产财产,并受制于第三方的债权,这些第三方享有优先于公众股东的债权的优先权。如果任何破产索赔耗尽了信托账户,就不能保证我们将能够向公共股东返还至少[·]美元(基于截至2023年[·]的信托账户余额)。保荐人签订的协议明确规定了其所提供的赔偿的两个例外情况:它不承担以下责任:(1)对所欠目标企业或供应商或其他实体的任何索赔金额,这些企业或供应商或其他实体已与我们签订协议,放弃他们在信托账户中或对信托账户中持有的任何款项可能拥有的任何权利、所有权、利息或任何类型的索赔,或(2)对IPO承销商针对某些责任(包括《证券法》规定的责任)提出的任何索赔。ACIC的独立注册会计师事务所Marcum LLP和此次IPO的承销商不会与ACIC签署协议,放弃对信托账户中资金的此类债权。
雇员
ACIC有三名执行官。这些人没有义务在ACIC事务上投入任何特定的时间,只在他们认为必要的时候投入ACIC事务。ACIC不打算在企业合并完成之前拥有任何全职员工。
法律程序
据ACIC管理层所知,目前没有针对ACIC、ACIC的任何高级管理人员或董事或ACIC的任何财产的未决或潜在诉讼。
193
Directors,OFFICERS,EXECUTIVE COMPENSATION AND CORPORATE GOVERNANCE OF ACIC PRIOR TO THE BUSINESS COMBINATION
董事和执行干事
ACIC现任董事和执行干事如下:
姓名 |
|
年龄 |
|
职务 |
Joel Shulman博士 |
56 |
董事长兼首席执行官 |
||
Eva Adosoglou |
32 |
首席运营官 |
||
Grant Grigorian |
60 |
首席财务官 |
||
Kevin Cramton |
62 |
董事 |
||
查尔斯·阿古拉斯 |
55 |
董事 |
||
Jeffrey Mortimer |
58 |
董事 |
我们的董事和执行人员的经验如下:
乔尔·M·舒尔曼博士自成立以来一直担任我们的董事长兼首席执行官。他还担任ERShares的创始人、董事总经理和首席信息官。ERShares是一家全球资产管理公司,拥有40多年投资创业上市公司的经验。他在巴布森学院从事了超过25年的研究,并著有一本在哈佛大学期间开发的畅销书,导致了专有投资模型和企业家因素的形成。舒尔曼博士之前创立并出售了《舒尔曼评论》,这是一家CFA的备考公司,在世界各地的许多国家培训了数千名投资专业人士。他为世界银行提供咨询服务,并帮助促进中亚国家资本市场的发展。舒尔曼经常出现在福克斯商业频道、CNBC、雅虎财经、彭博、《华尔街日报》、《巴伦周刊》和《福布斯》的媒体上。他拥有哈佛大学金融学博士学位、CFA特许持有人和MPA学位。
Eva Adosoglou自成立以来一直担任我们的首席运营官。自2021年初以来,她一直担任ERShares的首席运营官和首席投资策略师,负责投资组合策略、创新战略计划和整体运营。2018年10月至2019年7月,她担任GetSalesClub,Inc.的首席运营官。2018年5月至2018年9月,Adosoglou女士担任Wirecard GMBH的创新经理。2016年12月至2018年4月,她在Incadea/COX Automotive Inc担任投资组合分析师和战略项目项目项目经理。2016年6月,她还担任Adecco Group的全国首席执行官。2015年4月至2016年4月,她是谷歌初创公司Cosmocycle,Inc.的初创公司联合创始人。2011年9月至2013年5月,她担任普华永道财务审计员。Adosoglou女士是一位富布赖特学者,拥有丰富的领导经验,在欧洲和美国都有跨国和初创组织。她会说四种语言,拥有商业硕士学位,重点是创新和技术,并多次获得创业和领导力竞赛的冠军。Adosoglou女士在开发创新产品、扩大初创企业规模以及在以技术为基础的新公司环境中建立合作伙伴关系方面的丰富经验,为评估潜在投资提供了独特的定位。她热衷于投资于公共股票和女性主导的计划,并创建了两个新的投资战略:企业家医疗保健和技术以及女性主导的企业家。她是彭博、亚美利交易、福克斯商业和雅虎财经等主要商业网络的常客,还积极为千禧一代投资者和其他金融科技解决方案构建技术增强的投资模型和平台。她拥有雅典大学的学士学位和波士顿大学的硕士学位。
Grant Grigorian自成立以来一直担任我们的首席财务官。自2021年8月起,格里戈里安先生担任汽车零售技术公司CarSaver的首席财务官。他是一位在国际上经验丰富的金融领袖,曾在5个大洲生活和工作。1987年6月至2017年5月,他在福特汽车公司(纽约证券交易所代码:F)担任过多个职位,包括福特南非和阿根廷业务的首席财务官,以及汽车开发融资的全球财务总监。在2009年金融危机最严重的时候,他曾在福特财政部任职,推动下属机构制定现金保全计划,并采取行动将现金转移到美国或其他市场。格里戈里安还担任福特亚太地区的战略和业务发展主管,该职位包括与福特中国和日本合资伙伴的关系管理和谈判。他还曾在福特多家子公司和合资企业的董事会任职,包括担任审计委员会成员和董事长。2018年5月至2018年9月,他担任CarSaver的首席运营官/首席财务官。Grigorian先生于2019年4月至2020年10月担任车辆保修分销和管理公司National Automotive Experts/NWAN的首席财务官。
194
Kevin Cramton自2021年11月起担任我们的独立董事之一。克拉姆顿曾在5家不同的公司担任首席执行官和执行主席,包括多个地区的科技公司。自2019年12月起,他担任汽车零部件制造商Tribar Technologies Inc.的董事长兼首席执行官。2016年1月至2017年8月,Cramton先生担任Atlantix全球系统公司执行主席。2012年至2015年,他担任CARDONE Industries的首席执行官。2011年9月至2012年8月,他担任Revstone Industries,LLC(“Revstone”)的首席执行官。2012年12月,Revstone申请第11章破产。2009年至2011年,他担任Niles有限公司的执行主席。他拥有丰富的并购经验,完成了约50笔交易,企业价值达250亿美元。他曾领导福特的并购活动5年,自2007年1月以来一直在私人股本部门工作。克拉姆顿还拥有丰富的科技和金融服务经验,包括监督福特的科技资产风险投资组合,以及在福特的金融服务业务部门工作。他在许多不同的公司拥有广泛的董事会经验,包括多个业务部门和地区。自2019年6月以来,Cramton先生一直担任货运和物流公司Southern AG Carriers Inc.的董事。自2017年3月起,他担任Helmerich and Payne(纽约证券交易所代码:惠普)审计委员会成员,这是一家公共石油和天然气钻探公司。自2017年8月起,他担任TSMMFG董事。公司。他曾在日本公司朝日技术的董事会任职,该公司曾在东京证券交易所上市。
Charles Aggouras自2022年11月起担任我们的独立董事之一。自1998年以来,他一直担任总承包、房地产开发和投资公司GFC Development Inc.的总裁兼首席执行官。他拥有超过25年的丰富的房地产、金融和创业经验,涉及商业和住宅房地产市场的各个方面。作为注册代表,他曾为多家金融机构提供财务咨询、投资组合管理、遗产管理和退休规划服务。他于1990年获得萨福克大学会计和融资学士学位。
Jeffrey Mortimer自2021年11月起担任我们的独立董事之一。莫蒂默先生是纽约梅隆银行财富管理公司(纽约证券交易所代码:BK)的投资策略总监,并担任该公司投资策略委员会主席。Mortimer先生于1997年9月至2010年7月在Charles Schwab投资管理公司(纽约证券交易所代码:SCHW)担任多个职位,最终成为首席投资官。从1986年到1996年,他还在几家小型金融规划公司工作,为高净值客户、捐赠基金和家庭服务。Mortimer先生拥有巴布森学院金融学学士学位和芝加哥大学商学院工商管理硕士学位。他是CFA特许持有人。
干事和主任办公室的人数和任期
我们现在有四位董事。我们的董事会分为三个级别,每年只选出一个级别的董事,每个级别的董事任期为三年。
合并后的公司董事会将由七名董事组成,其中大多数董事将是独立董事,包括GIO在交易结束前指定的五名董事,其中至少三名董事将符合独立董事的资格,两名董事将符合独立董事的资格,另一名董事将由GIO和ACIC各自商定,批准将不会被无理拒绝或延迟,所有这些董事都必须符合独立董事的资格,交易结束后生效,在合并后公司董事会任职,直至合并后公司的年度会议,或该等董事的继任人已被正式选出并符合资格,或该等董事较早前去世、辞职、退休或因故被免职。ACIC提议股东批准在合并完成后选举七名被提名的董事担任合并后的公司董事会成员。董事选举提案正提交ACIC股东审议和表决。
我们的官员由董事会任命,由董事会酌情决定,而不是根据具体的任期任职。本公司董事会获授权委任其认为适当的人士出任本公司附例所列的职位。我们的章程规定,我们的管理人员可由董事会主席、首席执行官、首席财务官、总裁、副总裁、秘书、财务主管、助理秘书以及董事会可能决定的其他职位组成。
董事独立性
我们的董事会已经确定,Kevin Cramton、查尔斯阿古拉斯和Jeffrey Mortimer是美国证交会规定的“独立董事”。我们的独立董事定期举行只有独立董事出席的会议。
195
行政协调会理事会各委员会
我们的董事会有三个常设委员会:一个审计委员会、一个薪酬委员会和一个提名和公司治理委员会。
审计委员会
我们设立了一个董事会审计委员会。Kevin Cramton、查尔斯·阿古拉斯和Jeffrey Mortimer担任审计委员会成员,Kevin Cramton担任审计委员会主席。我们审计委员会的所有成员都独立于我们的保荐人和承销商,与之无关。
审计委员会的每一位成员都具有财务知识,我们的董事会已确定Kevin Cramton符合适用的SEC规则所定义的“审计委员会财务专家”的资格,并具有会计或相关的财务管理专业知识。
我们通过了审计委员会章程,其中详细规定了审计委员会的主要职能,包括:
| ● | 协助董事会监督(1)我们的财务报表的完整性,(2)我们遵守法律和监管规定,(3)我们的独立注册会计师事务所的资格和独立性,以及(4)我们的内部审计职能和独立注册会计师事务所的履行情况;独立审计师和我们聘用的任何其他独立注册会计师事务所的任命、报酬、保留、更换和监督工作; |
| ● | 预先批准由独立审计师或我们聘用的任何其他注册会计师事务所提供的所有审计和非审计服务,并制定预先批准的政策和程序;审查并与独立注册会计师事务所讨论审计师与我们的所有关系,以评估他们的持续独立性; |
| ● | 根据适用的法律和条例,为审计合伙人的轮换制定明确的政策;至少每年从独立注册会计师事务所获得并审查一份报告,说明(1)独立注册会计师事务所的内部质量控制程序;(2)在过去五年内,对该会计师事务所进行的一次或多次独立审计以及为处理此类问题而采取的任何步骤,由该会计师事务所最近一次内部质量控制审查或同行审查或政府或专业机构的任何调查或调查所提出的任何重大问题; |
| ● | 与管理层和独立审计师开会审查和讨论我们的年度审计财务报表和季度财务报表,包括审查我们在“管理层对财务状况和经营成果的讨论和分析”下的具体披露; |
| ● | 审查和批准根据美国证交会颁布的S-K条例第404项要求披露的任何关联方交易,然后再进行此类交易;以及 |
| ● | 与管理层、独立注册会计师事务所和我们的法律顾问(视情况而定)一起审查任何法律、监管或合规事项,包括与监管机构或政府机构的任何通信,以及对我们的财务报表或会计政策提出重大问题的任何员工投诉或发布的报告,以及财务会计准则委员会、美国证券交易委员会或其他监管机构颁布的会计准则或规则的任何重大变化。 |
薪酬委员会
我们已经成立了一个董事会薪酬委员会。Jeffrey Mortimer和Kevin Cramton是我们薪酬委员会的成员。根据适用的SEC规则,该委员会的所有董事都必须是独立的。我们的董事会已经决定,Jeffrey Mortimer和Kevin Cramton都是独立的,Jeffrey Mortimer是薪酬委员会的主席。
196
我们已通过薪酬委员会章程,其中详述了薪酬委员会的主要职能,包括:
| ● | 每年审查和批准与首席执行官和首席财务官薪酬有关的整体目标和目标,根据这些目标和目标评估首席执行官和首席财务官的业绩,并根据这些评估确定和批准首席执行官和首席财务官的薪酬(如果有的话); |
| ● | 审查并向董事会提出有关薪酬的建议,以及任何激励薪酬和基于股权的计划,这些计划须经董事会所有其他高级职员批准; |
| ● | 审查我们的高管薪酬政策和计划; |
| ● | 实施和管理我们基于股权的激励薪酬计划; |
| ● | 协助管理层遵守我们的委托书和年报披露要求; |
| ● | 批准我们的管理人员和雇员的所有特别津贴、特别现金付款和其他特别薪酬和福利安排; |
| ● | 制作一份有关高管薪酬的报告,并将其纳入我们的年度代理声明;以及 |
| ● | 对董事薪酬进行审查、评估,并酌情提出修改建议。 |
尽管如此,如上所述,除了支付给我们的赞助商每月10000美元,最多15个月,用于办公空间、水电费、秘书和行政支助以及报销费用外,我们的任何现有股东、高级管理人员、董事或他们各自的任何关联公司在完成初始业务合并之前,或为他们提供的任何服务,都不会得到任何形式的补偿,包括发现者、咨询费或其他类似费用。因此,在初步业务合并完成之前,赔偿委员会很可能只负责审查和建议与此种初步业务合并有关的任何赔偿安排。
章程还规定,薪酬委员会可自行决定保留或征求薪酬顾问、独立法律顾问或其他顾问的意见,并将直接负责任何此类顾问的任命、薪酬和监督工作。然而,在聘用或接受薪酬顾问、外部法律顾问或任何其他顾问的建议之前,薪酬委员会将考虑每个此类顾问的独立性,包括证交会和适用交易所要求的因素。
提名和公司治理委员会
我们已经成立了董事会的提名和公司治理委员会,Jeffrey Mortimer和查尔斯阿古拉斯担任我们的提名和公司治理委员会的成员。
我们的董事会已经决定,Mortimer先生和Aggouras先生都是独立的,而Aggouras先生是提名和公司治理委员会的主席。
我们的提名及企业管治委员会的主要目的是协助董事会:
| ● | 物色、筛选和审查有资格担任董事的个人,并向董事会推荐候选人,供股东年会提名选举或填补董事会空缺; |
| ● | 制定并向董事会提出建议,并监督公司治理准则的实施; |
197
| ● | 协调和监督董事会、各委员会、个别董事和管理层在公司治理方面的年度自我评估;以及 |
| ● | 定期审查我们的公司治理,并在必要时提出改进建议。 |
我们的提名和公司治理委员会将向董事会推荐候选人,供股东年会选举。
我们没有正式确定任何必须达到的具体的、最低限度的资格或董事必须具备的技能。一般来说,在确定和评估董事候选人时,董事会会考虑教育背景、专业经验的多样性、对我们业务的了解、诚信、专业声誉、独立性、智慧以及代表股东最大利益的能力。
董事提名
ACIC董事会亦会考虑股东推荐的董事候选人,以供他们在下一次股东年会(或如适用的话,特别股东大会)上提名候选人。我们的股东如果希望提名一名董事参加ACIC董事会的选举,应该遵循ACIC章程中规定的程序。
我们没有正式确定任何必须达到的具体的、最低限度的资格或董事必须具备的技能。一般来说,在确定和评估董事候选人时,董事会会考虑教育背景、专业经验的多样性、对我们业务的了解、诚信、专业声誉、独立性、智慧以及代表股东最大利益的能力。
Code of Ethics
我们通过了适用于我们的董事、管理人员和雇员的Code of Ethics。我们已经提交了一份《Code of Ethics》和审计委员会及薪酬委员会章程的副本。您可以通过访问我们在美国证交会网站www.sec.gov上的公开文件来查看这份文件。此外,应我们的要求,我们将免费提供《Code of Ethics》和各委员会章程的副本。如果我们对《Code of Ethics》作出任何修订,但不是技术性、行政性或其他非实质性修订,或对适用于我们的首席执行官、首席财务官、首席会计官或控制人或履行类似职能的人的《Code of Ethics》条款作出任何豁免,包括任何隐性豁免,我们将在我们的网站上披露此类修订或豁免的性质。我们网站上包含的信息并未通过引用并入本委托书/招股说明书或我们向SEC提交的任何其他报告或文件中,对我们网站的任何引用仅作为无效的文本引用。
198
Management’s Discussion and Analysis of FINANCIAL CONDITION AND RESULTS OF OPERATION OF ACIC
除非上下文另有要求,本节中对“公司”、“我们”、“我们”或“我们的”的所有引用均指完成业务合并之前的ACIC。以下关于ACIC财务状况和业务结果的讨论和分析,应与ACIC的审定财务报表以及本委托书/说明书其他部分所载的有关说明一并阅读。下文讨论和分析中包含的某些信息包括涉及风险和不确定性的前瞻性陈述。由于许多因素,我们的实际结果可能与这些前瞻性陈述中的预期存在重大差异。请参阅本委托书/招股说明书中题为“关于前瞻性陈述的注意事项”和“风险因素”的章节。
概述
我们是一家空白支票公司,于2020年12月28日根据特拉华州法律成立,目的是实现与一个或多个企业的业务合并。我们打算利用我们的首次公开发行和出售私人认股权证、我们的证券、债务或现金、证券和我们的债务的组合所产生的现金来实现我们的业务合并。公司最初有15个月的时间从IPO结束,或者到2023年2月12日,完成业务合并。
2022年12月21日,我们召开了2022年特别会议,股东们在会上批准了对我们经修订和重述的公司注册证书的修订,将我们完成初始业务合并的日期从2023年2月12日延长至2023年8月14日。就延期而言,持有15,747,797股A类普通股的股东行使了按比例赎回信托账户资金的权利。在赎回之后,我们有1,502,203股公众股发行在外。这导致从信托账户支付约162131529美元,其中716610美元在2023年支付。
我们预计在执行我们的收购计划过程中将继续产生大量成本。我们不能向你方保证,我们完成业务合并的计划一定会成功。
经营成果
到目前为止,我们既没有从事任何业务,也没有产生任何收入。从2020年12月28日(成立)到2022年12月31日,我们唯一的活动是组织活动,这些活动是为我们的首次公开发行做准备所必需的,如下所述,以及为业务合并确定目标公司。在我们的业务合并完成之前,我们预计不会产生任何营业收入。我们以信托账户中持有的有价证券的利息收入的形式产生营业外收入。由于我们是一家上市公司(在法律、财务报告、会计和审计合规方面),以及在寻找和完成业务合并方面的尽职调查费用,我们产生了费用。
截至2022年12月31日止年度,我们的净收入为6582898美元,其中包括认股权证负债的公允价值变动6057000美元和信托账户中持有的有价证券所赚取的利息2318006美元,由1203615美元的运营和组建成本以及588493美元的所得税准备金抵消。
在2021年1月1日至2021年12月31日期间,我们的净收入为486473美元,其中包括认股权证负债的公允价值变动1087250美元和信托账户中持有的有价证券所赚取的利息2082美元,与我们的首次公开发行相关的交易成本368544美元以及运营和组建成本234315美元。
流动性和资本资源
2021年11月12日,我们完成了17,250,000个单位的首次公开发行,其中包括承销商以每单位10.00美元的价格全额行使其2,250,000个单位的超额配股权,总收益为172,500,000美元。在我们完成首次公开发行的同时,我们完成了以每份私募认股权证1.00美元的价格向保荐人和Cantor(我们首次公开发行的承销商(“承销商”)的代表)出售8,200,000份私募认股权证,产生了8,200,000美元的总收益。
199
在我们于2021年11月12日进行首次公开发行(包括完全行使超额配股权和私募)之后,我们在信托账户中总共存入了175,950,000美元(或每单位10.20美元)。我们的首次公开发行相关费用为12644008美元,其中包括3000000美元的承销费(扣除偿还费用后的净额)、9075000美元的递延承销费和569008美元的其他发行费用。
截至2022年12月31日止年度,用于经营活动的现金为329808美元。净收入6582898美元是由于权证负债公允价值变动6057000美元和信托账户中持有的有价证券所赚取的利息2318006美元。业务资产和负债的变动将1462300美元现金用于业务活动。
截至2022年12月31日止年度,用于经营活动的现金为454420美元。486473美元的净收入受到权证负债公允价值变动1087250美元、信托账户持有的有价证券赚取的利息2082美元以及与首次公开发行有关的交易费用368544美元的影响。业务资产和负债的变动将220105美元现金用于业务活动。
截至2022年12月31日,我们在信托账户中持有的现金为16182549美元(包括大约1647468美元的利息收入)。信托账户余额的利息收入可能被我们用来纳税。在截至2022年12月31日的一年中,我们从信托账户中提取了672620美元,用于支付特许经营税和所得税,并为与延期有关的赎回支付了161414919美元。
我们打算利用信托账户中持有的几乎所有资金,包括信托账户上赚取的任何利息(减去递延承销佣金和应付所得税),来完成我们的业务合并。如果我们的股本或债务被全部或部分用作完成业务合并的对价,信托账户中持有的剩余收益将被用作营运资金,为目标业务或业务的运营提供资金,进行其他收购,并实施我们的增长战略。
截至2022年12月31日,我们的现金为1,094,384美元。我们打算将信托账户以外的资金主要用于识别和评估目标企业,对潜在目标企业进行业务尽职调查,往返于潜在目标企业或其代表或所有者的办公室、工厂或类似地点,审查潜在目标企业的公司文件和重要协议,以及组织、谈判和完成企业合并。
为了弥补营运资金不足或为与企业合并相关的交易成本提供资金,我们的保荐人或我们的某些高级职员和董事或他们的关联公司可以(但没有义务)根据需要向我们提供贷款。如果我们完成一项业务合并,我们将偿还这些贷款。如果企业合并没有结束,我们可以使用信托账户以外的部分周转资金来偿还这些贷款,但我们信托账户的收益不会用于偿还。这种周转贷款中最多可有1500000美元可兑换成业务合并后实体的权证,每份权证的价格为1.00美元。认股权证将与私募认股权证相同。
我们可能需要通过从我们的发起人、股东、高级职员、董事或第三方的贷款或额外投资来筹集额外的资金。我们的管理人员、董事和保荐人可以(但没有义务)不时或在任何时候,以他们认为合理的数额,为满足我们的营运资金需求而向我们提供贷款。因此,我们可能无法获得额外的资金。如果我们无法筹集更多资金,我们可能需要采取更多措施来节省流动性,这些措施可能包括但不一定限于减少业务、暂停进行潜在的交易以及减少管理费用。我们不能保证,如果有的话,我们将以商业上可接受的条件获得新的资金。这些条件令人严重怀疑,如果企业合并未能完成,公司是否有能力从本代理声明/招股说明书其他部分所载财务报表之日起持续经营一年。本委托书/说明书其他部分所载的财务报表不包括在我们不能继续作为经营中企业时可能需要的与收回记录资产或负债分类有关的任何调整。
合同义务
我们没有任何长期债务义务、资本租赁义务、经营租赁义务或其他长期负债,只是同意每月向我们的赞助者支付总计高达10000美元的办公空间、水电费以及秘书和行政支助。我们从2021年11月8日开始产生这些费用,并将继续每月产生这些费用,直至完成业务合并和我们的清算(以较早者为准)。
200
我们首次公开发行的承销商有权收取递延费用:(一)在我们首次公开发行中售出的15,000,000个单位中,每单位0.50美元,或总计7,500,000美元;(二)根据超额配股权售出的每单位0.70美元,或总计1,575,000美元。递延费用将从信托账户中持有的金额中支付给承销商,仅在我们完成业务合并时支付,但须遵守承销协议的条款。
关键会计政策
按照公认会计原则编制财务报表和相关披露要求管理层作出估计和假设,这些估计和假设会影响所报告的资产和负债数额、在财务报表日期披露的或有资产和负债以及所报告期间的收入和支出。实际结果可能与这些估计数大不相同。我们确定了以下关键会计政策:
认股权证负债
我们根据ASC主题815-40-15-7D“衍生工具和套期保值”中的指导意见,对与首次公开发行有关的认股权证进行会计处理,根据该指导意见,认股权证不符合权益处理标准,必须记为负债。因此,我们将认股权证按其公允价值归类为负债,并在每个报告期将认股权证按公允价值调整。该负债须在每个资产负债表日重新计量,直至行使,公允价值的任何变动均在我们的经营报表中确认。
可予赎回的A类普通股
我们根据ASC主题480“区分负债与权益”中的指导,对可能赎回的A类普通股进行会计处理。强制赎回的A类普通股被归类为一种负债工具,以公允价值计量。有条件赎回的A类普通股(包括具有赎回权的A类普通股,这些赎回权要么在持有人的控制范围内,要么在发生不确定事件时可以赎回,而不仅仅是在我们的控制范围内)被归类为临时股权。在其他任何时候,普通股都被归为股东权益。我们的A类普通股具有某些赎回权,这些赎回权被认为超出了我们的控制范围,可能会发生不确定的未来事件。因此,可能被赎回的A类普通股以赎回价值作为临时权益列报,不包括在我们资产负债表的股东赤字部分。
每股普通股净收入
每股普通股净收入的计算方法是将净收入除以该期间已发行普通股的加权平均数。我们在计算每股收益时采用了二分类法。与A类普通股可赎回股份相关的增值不计入每股收益,因为赎回价值接近公允价值。
最近的会计准则
管理层认为,最近颁布但尚未生效的任何其他会计准则,如果目前获得通过,将不会对我们的财务报表产生重大影响。
可能对我们的经营业绩产生不利影响的因素
我们的业务结果和我们完成初步业务合并的能力可能受到各种因素的不利影响,这些因素可能导致经济不确定性和金融市场的波动,其中许多因素是我们无法控制的。除其他外,我们的业务可能受到以下因素的影响:金融市场或经济状况低迷、油价上涨、通货膨胀、利率上升、供应链中断、消费者信心和支出下降、新冠疫情的持续影响,包括死灰复燃和新变种的出现,以及地缘政治不稳定,例如乌克兰的军事冲突。我们目前无法完全预测上述事件中的一个或多个事件的可能性、其持续时间或程度,或它们可能对我们的业务和我们完成初始业务合并的能力产生负面影响的程度。
201
关于GIO的信息
除非文意另有所指,本节中所有提及的“GIO”、“我们”、“我们的”、“我们”或“公司”均指企业合并完成前的公司及其全资子公司,或合并后的公司及其子公司。我们计划在因各种因素而面临高度不确定性和风险的行业和领域开展业务,包括标题为“风险因素”一节和本委托书/招股说明书其他部分所述的那些因素。我们在本节和本代理声明/招股说明书其他部分所述的产品和服务的开发和创收计划可能无法按计划实现,或者我们的计划可能会因各种已知和未知的原因而改变,其中许多原因不在ACIC和我们的控制范围内,无法预测,这些因素和其他因素可能导致业务、运营、计划和结果与GIO的计划存在重大差异。我们可能无法开发或建立我们计划的部分或全部业务线,或者,如果我们继续执行本节和本代理声明/招股说明书其他部分所述的业务线,则无法保证我们将能够从中获得收入或成功地与从事类似业务的其他公司竞争。本节中包含的某些信息具有前瞻性,在阅读和考虑这些信息的同时,还应审阅这份委托书/招股说明书中题为“关于前瞻性陈述的注意事项”和“风险因素”的章节。
概述
GIO是一家处于发展阶段的生命科学公司,打算在全球开发和分销精选的基于干细胞的产品和服务。由我们的官员控制的实体,也是我们的最大股东,全球干细胞治疗和研究公司(简称“GIOSTAR”),已授予我们独家许可(受GIOSTAR在下述某些地区保留的某些剥离权利的限制),使用GIOSTAR的所有商业秘密、专有技术和其他机密和专有信息,包括发明、协议、工艺、配方、数据、研究结果和专有技术,在四个干细胞相关领域开发和商业化产品和服务:通用捐赠红细胞、抗衰老、活性化妆品和COVID治疗。有关我们与GIOSTAR的许可协议的更多信息,请参阅下面的“GIOSTAR许可协议”。此外,在交割时,我们将与GIOSTAR签订供应协议(“GIOSTAR供应协议”),根据该协议,GIOSTAR将向我们提供其成人人类干细胞衍生分子产品(“AHSDM”,也称为“活性成分”),如下文进一步讨论。
我们目前的战略重点是在三个主要部门或“业务线”开发产品和服务:以干细胞疗法为特色的抗衰老诊所(“抗衰老诊所”);大规模生产通用供体红细胞(“通用红细胞”);销售用于开发、制造和销售化妆品或护肤品的AHSDM(“活性化妆品”)。虽然我们并不认为它是我们主要关注的领域之一,但GIOSTAR还授予我们使用其干细胞技术进行COVID相关疗法的独家许可。
本章标题为“概述”的三个业务线中的每一个目前都是预期性质的,因为我们目前没有业务、产品或服务,我们目前也没有从这三个业务线中的任何一个获得任何收入。我们可能同时或依次对三个业务线的部分或全部,或部分或全部的某些方面进行进一步开发,这取决于包括但不限于获得资本、监管考虑和其他事项的因素,如下文和本代理声明/招股说明书中题为“风险因素——与GIO业务相关的风险”的部分进一步描述。鉴于我们尚未开始运营,我们在进行与未来潜在业务线相关的业务活动时,可能会遇到风险和挑战,包括我们无法预见且不在我们控制范围内的情况或事件,这些风险和挑战会使我们对部分或全部业务线或其中的重要元素的追求比我们预期的更加困难或不可能,在这种情况下(或出于其他原因),我们可能会改变或修改我们所从事的业务活动,以便建立和发展我们的业务,也许是实质性的,我们最终追求或建立的业务可能与本代理声明/招股说明书中标题为“关于GIO的信息”的部分和其他部分对业务线的描述有很大不同。投资者不应依赖本“关于GIO的信息”中包含的信息作为GIO当前或截至任何其他日期的实际业务的指示性或代表性,因为我们的计划可能会发生变化。在阅读标题为“关于GIO的信息”的这一节中包含的所有信息时,应仔细检查和审查与GIO和潜在业务线相关的各种风险和不确定性,包括本注册/代理声明中标题为“风险因素”、“GIO管理层对财务状况和运营结果的讨论和分析”和“关于前瞻性声明的注意事项”的章节中所述的风险和不确定性。
202
我们的战略
我们的长期目标是成为一家领先的以干细胞为基础的生命科学公司,专注于开发和商业化以干细胞为基础的产品和服务。我们为实现我们的目标而打算实施的战略的关键要素包括:
| ● | 与现有医疗实践建立伙伴关系,并探索建立GIO拥有的抗衰老诊所。我们计划寻求与现有的医疗实践和诊所建立伙伴关系 位于美国以外的司法管辖区(在所有情况下,均须核查是否符合任何必要的监管和营销批准要求(如适用)),以便签订许可、收入分享或类似安排,以进行基于间充质干细胞(“MSC”)的治疗,其过程和方法已由GIOSTAR授权给我们,供我们在某些排除在外的地区以外独家使用。如果我们成功地建立了这种伙伴关系或安排,GIO管理层相信,这样的业务模式可以产生潜在收入,但给我们带来的相关间接费用有限(与通常与所有者/经营者业务模式相关的费用相比)。阿南德博士和帕特尔先生致力于利用他们的专业网络,在我们可以进行基于MSC的治疗的司法管辖区开展这些合作。在获得必要的资金和其他资源的前提下,我们可能还会探索机会,开发GIO拥有的抗衰老诊所,在美国以外的主要市场提供基于MSC的治疗。如果我们将来能够建立、拥有和经营这些诊所,我们可以雇用医生、护士、科学家和辅助人员来经营这些诊所。 |
| ● | 推进我们的通用红细胞的开发和生产能力,并在其他司法管辖区进行临床试验.我们目前正在探索各种途径,以促进构建被称为“生物反应器”的科学设备的原型。“生物反应器”是一种制造的设备或系统,支持生物活性环境,除其他外,影响细胞的生长和分化(如下文进一步描述)。GIO管理层已确定,在设计和创建这些设备时,可以利用GIOSTAR授权给我们的专有技术、商业秘密和相关知识产权,用于大规模的通用红细胞生产。我们预计,在创建此类生物反应器的同时,我们将进一步开发这些设备或系统。如果我们创建原型生物反应器的计划获得成功,我们的目标是争取FDA批准此类技术、程序和通用RBC。同时,我们也可能在美国以外的司法管辖区销售通用红细胞或我们可能利用此类技术和程序开发的任何产品,在这些司法管辖区销售和营销此类产品可能被允许,直到我们满足所需的测试、试验、安全性和其他条件,才能获得FDA和其他批准,这些批准可能是在美国销售和销售通用红细胞所必需的。我们生产通用红细胞的目的是解决全世界每年估计约有1亿单位(品脱)血液短缺的问题,这些血液需要用于各种医疗程序、应急方案、政府和军事用途以及研究和开发目的。假设我们有能力生产我们的通用红细胞并获得FDA和其他适用的监管批准,我们计划向全球政府、医院、医疗服务提供商和其他潜在客户推销我们的通用红细胞,目标是帮助解决全球献血者血液短缺问题。 |
| ● | 生产我们的活性化妆品产品并与化妆品供应商建立战略关系.我们计划将AHSDM作为所谓的“活性成分”出售,以纳入现有公司的化妆品或护肤品,但需视市场状况和需求而定。在这方面,我们预计最初将出售根据GIOSTAR供应协议提供给我们的AHSDM,这是朝着开发和商业化活性化妆品业务线的目标迈出的基础一步。随着时间的推移,我们预计会发展内部能力,在内部创造和制造“活性成分”,前提是我们能够获得必要的资金和其他资源。随着时间的推移,我们可能还会继续开发我们自己的Active Cosmetics系列产品,其中包含AHSDM或我们可能会随着时间的推移或不时开发的其他“活性”成分,在每种情况下,都取决于所需资源的可用性和满足情况下适用的监管和营销批准。我们认为可以成功纳入AHSDM的“活性化妆品”产品类型可能包括但不限于抗皱产品、面部精华液、日间护肤霜、眼底抗皱精华液、高端面霜和头发活力配方;但前提是我们尚未对AHSDM进行功效或安全性测试或研究或涉及AHSDM或它们可能被纳入或作为“活性”成分用于其他产品的方式。在获得适当资源的情况下,我们还计划独立或与第三方合作者进行测试或消费者试验,以期展示将AHSDM作为“活性”成分加入这些和其他类型产品的好处。 |
| ● | 执行可能出现的研发和商业化机会,以最大限度地发挥GIOSTAR授权给我们的专利干细胞技术的价值.作为我们发展努力的一个目标,我们力求使根据《公约》授权给我们的干细胞技术的价值最大化,包括从商业角度来看。 |
203
| GIOSTAR许可协议,结合内部开发,并在我们可以获得的情况下,以及在适当的情况下,精心挑选的合作机会(视将来可能出现)。 |
干细胞和基于干细胞的产品和服务的科学概述
干细胞是一组特殊的未分化细胞,尚未发育出特定类型细胞或组织的特征结构或蛋白质。干细胞有能力分裂形成更多的细胞,称为“子细胞”。这些子细胞要么成为新的干细胞(未分化),要么成为具有更特殊功能的特化细胞(已分化),如血细胞、脑细胞、肌肉或组织细胞或骨细胞。干细胞构成了一组独特的细胞,其特征是不确定的分裂和分化成不同的特化身体细胞。干细胞分化为不同类型细胞的能力各不相同。身体中其他类型的成体细胞不具有生成新细胞类型的自然能力;因此,干细胞有助于在人体中生成所有成熟细胞,是每个细胞、组织和器官的基础。
干细胞的发现开启了再生医学领域的新篇章,并在过去40年里激发了该领域的积极研究。目前正在进行各种体外、体内研究和临床试验,以测试几种病理状况,包括心脏、眼睛、肾脏、关节和血液疾病。干细胞以几种方式发挥作用,这些方式可能对病理状况有所帮助,包括干细胞在受损组织中的迁移和沉降。因为干细胞可以在宿主组织的细胞类型中分化,它们可以帮助促进受损组织的恢复。
抗衰老诊所
概览–战略和业务项目计划
老龄化是一个不可避免的过程,可以推迟,但无法避免。衰老是疾病的一个重要触发因素,在许多情况下往往会加剧和扩大其不良影响,往往影响视力、听力、肌肉力量、骨量、免疫力和神经功能,在某些情况下,还会诱发或促成各种代谢紊乱。
GIOSTAR已授予我们使用其专有技术和商业秘密的许可,包括但不限于与基于MSC的疗法和GIOSTAR可能不时开发的任何其他疗法或产品相关的技术和商业秘密(与我们可能不时开发的任何相关技术和商业秘密或其他专有信息和技术合称为“抗衰老疗法”),用于我们在美国以外地区开发抗衰老诊所业务线,但须遵守这些地区(墨西哥、印度和哥斯达黎加以外的“被排除在外地区”)的监管要求(如适用)。我们相信,获得许可的技术诀窍和商业秘密,包括但不限于Srivastava医生用来处理干细胞的技术、过程中的步骤以及所需化学物质的测量,这些技术创造了患者干细胞提取后添加到基础配方中的基础配方,了解了根据特定患者的需求对基础配方进行调整的知识,以及Srivastava医生在干细胞科学方面的丰富经验,为我们提供了发展这一业务线所需的工具。我们预计最初的目标是美国以外的地方,我们认为适用的监管要求允许提供我们的抗衰老疗法,广告和销售基于干细胞的产品和服务。
我们的抗衰老疗法试图通过将MSCs引入受损细胞区域来解决与衰老相关的复杂问题。简单来说,我们的抗衰老疗法包括三个主要步骤:(1)从体脂组织(或脂肪组织)、体内循环的血液、骨髓或脐带中分离MSCs;(2)将这些干细胞添加到我们专有的基本配方中,该配方通常适用于所有患者,并针对每个特定患者进行调整;(3)使用静脉注射(IV)途径或在受损组织局部注入干细胞。脂肪组织衍生的间充质干细胞比其他来源的间充质干细胞具有显著的优势,因为它们是从微创吸脂手术中获得的。脂肪组织含有大量的MSCs,并且由于皮下脂肪组织的可及性和易于提取的体积,可以获得大量的MSC。
我们相信,我们的抗衰老疗法可以为患者和临床客户提供额外的干细胞,从而潜在地减少炎症,促进受损细胞的再生,从而增强人体自愈的自然能力。我们的抗衰老疗法可能被用于治疗老化的关节、受损的肌肉、矫形问题和其他与年龄有关的并发症。
我们设想在未来建立一个抗衰老诊所网络,除抗衰老疗法外,还可能提供我们可能开发的其他抗衰老产品和服务,可能包括我们的活性化妆品产品,如下文所述。关于抗衰老疗法,我们预计抗衰老诊所将至少在一开始提供具有共同
204
常见的基础“基础配方”通常适用于所有患者,我们希望定制该“基础配方”以满足每位患者的特定需求(我们希望主要通过将患者自己的脂肪干细胞分离分子纳入“基础配方”来实现)。我们相信,采用通用的“基础配方”将提高我们抗衰老疗法的管理效率,并简化我们配方的生产,同时仍允许根据具体情况进行定制。
我们可能会为我们的抗衰老诊所业务线寻求两种可能的商业模式中的一种或两种,我们可能会同时或依次寻求,这取决于我们能够发展的关系以及其他战略和财务考虑。我们正在考虑的一种商业模式是与美国以外的现有或即将建立的医疗实践或其他临床治疗办公室和诊所合作(“诊所合作伙伴”)。Clinic Partners将提供我们的抗衰老疗法,并可能销售我们的抗衰老和活性化妆品产品,然后根据许可或特许经营安排与我们分享他们从这些产品和服务中获得的收入。如果我们采用这种模式,我们将计划,作为与Clinic Partners协议的一部分,向Clinic Partners提供GIOSTAR授权给我们的基于MSC的抗衰老治疗方案,用于分离和储存来自不同组织的MSC,对干细胞和MSC的注射途径进行质量检查。我们还计划在可能的情况下,协调在他们的诊所安装一套能够产生抗衰老疗法干细胞混合物的实验室。此外,我们会训练有关的医疗或其他临床专业人士了解我们的专业知识。在许多情况下,护士或其他适当的人,在必要的监督下,在所有情况下,受监管考虑、医疗或诊所执照要求和其他相关因素的影响,可能能够在医生或其他合格人员的指导下管理我们的抗衰老疗法的某些方面,例如干细胞的注入,这可能会降低手术的成本,并使我们的抗衰老疗法可供更广泛的人群使用。我们希望利用我们的管理团队在医学界的关系,他们在干细胞行业的职业生涯中发展起来的关系,来物色美国以外的潜在诊所合作伙伴(尽管我们尚未正式向此类诊所合作伙伴提供潜在的诊所业务)。
我们可能追求的第二种商业模式是在美国以外的市场建立和运营我们自己的GIO拥有的抗衰老诊所。如果我们采用这种方法,我们将雇用和培训我们自己的合格专业人员,这些专业人员根据适用的监管要求,有资格为患者管理我们的抗衰老疗法;而且,与我们的许可模式一样,我们还将在我们的抗衰老诊所销售我们的活性化妆品产品和抗衰老产品(如果有的话)。在第二种业务模式下,我们计划为我们的抗衰老诊所配备医生、护士和技术人员,他们已经在静脉注射方面接受过基本培训和经验,然后向这些人员提供有关我们抗衰老疗法和专门知识的培训和指导。我们还预计将雇用和培训具有基本细胞培养技能的技术人员,为我们的干细胞配方准备输液,这可能会提高培训过程的效率,并可能有助于加快建立我们的抗衰老诊所。我们对抗衰老诊所的设想是在一栋楼里完成治疗,包括接待区、医生和员工办公室、手术室、恢复室和干细胞实验室。随着我们扩大抗衰老诊所,我们希望最终有当地的运营经理来监督和管理我们的诊所。
全球评价组织作为一个实体,迄今尚未开始努力通过诊所伙伴或其他方式建立抗衰老诊所。此外,尽管GIO之前没有拥有、经营或与抗衰老诊所达成合作安排的经验,但GIOSTAR的附属公司和我们的管理团队目前经营着一条涉及抗衰老诊所的类似业务线,并从GIOSTAR授权给我们的经验中获得了宝贵的专业知识,包括但不限于开设新诊所的步骤、患者接收流程、测试(患者和干细胞,在输液前后)技术、与患者沟通的方式和招聘策略。根据GIOSTAR许可协议,我们被禁止在印度、哥斯达黎加和墨西哥开设抗衰老诊所。我们预计在抗衰老诊所方面将面临来自其他公司的竞争,如下文“竞争”部分所述。
市场机会
抗衰老疗法市场规模庞大且种类繁多,GIO管理层认为,该市场在全球增长方面还有很长的路要走。这一增长可能是由于不同性别和所有年龄的人今后对病人的需求增加,这似乎是可能的,因为病人的认识提高了,抗衰老疗法在年轻病人中越来越受欢迎。根据InsightAce Analytic的数据,2022年全球抗衰老疗法市场价值约为5.92亿美元,预计到2031年将增长至约24亿美元。抗衰老疗法的市场在一定程度上似乎受到了几个因素的推动,包括消费者对抗衰老疗法的需求上升、生活方式标准的提高以及世界人口收入的增加。
205
衰老和干细胞治疗
衰老是一个复杂的过程,其特点是身体功能下降,其特点是皮肤失去弹性,积累不想要的脂肪,增加动脉粥样硬化的发生率,免疫系统功能下降,增加骨骼的脆性(使他们容易骨折),并最终死亡。衰老的速度是由遗传、非遗传和其他环境因素的复杂相互作用决定的。最终,所有这些因素,不管是已知的还是未知的,都会在干细胞核心积累衰老的信息,并对延长寿命的基因产生不利影响。因此,所有的衰老现象都可以部分归因于干细胞的丧失,而干细胞是身体的再生基石。鉴于干细胞的核心作用和一般属性,它们可能构成一种“备份系统”,供生物体替换受损组织或老化细胞,从而使干细胞有可能成为决定衰老速度的核心因素。我们的专利碱基配方将寻求减少炎症过程和加强再生退化器官的身体利用干细胞的自然特性。
衰老是由一系列复杂的特定信号级联调控的。例如,干细胞使用胰岛素样生长因子1(IGF1)进行修复和再生。这种生长因子的过度表达或活性升高是改善肌肉再生所必需的。生长激素的信号传导事件是控制组织增殖和发育所必需的。干细胞已被证明是一个循环激素储存库,能够抑制IFG1通路延长小鼠的寿命。荷尔蒙信号通路是寿命的极其有效的调节剂,它们通过与其他通路一起以系统方式发挥作用,协调几个关键器官的寿命。抗衰老治疗可能有可能增加干细胞的数量和质量,也能够激活受者的再生信号。再生干细胞或抗衰老辅助疗法可能通过改善免疫年轻化和修复功能的过程来减缓或逆转这一过程。
MSCs靶向特定组织,以响应来自损伤组织的信号分子,这些分子激活干细胞中的相应受体。利用信号提示,已证明MSCs能够对身体的各种情况做出反应,包括在某些情况下对受伤的组织做出反应。受损组织分泌细胞因子和生长因子,吸引干细胞参与并促进再生。某些生长因子被证明可以诱导归巢干细胞进入身体的受伤区域。它们还通过吸引干细胞来刺激血管的形成。另一种信号分子,骨形态发生蛋白(BMP),已被证明可以将干细胞的细胞运输转移到骨形成。
干细胞通常会迁移到组织损伤的地方,并协调救援行动。干细胞成为驻留组织的再生部分,但除此之外,再生效应是由于其分泌的细胞因子和生长因子对损伤的反应。此外,干细胞与局部组织沟通,并指导其储备细胞和介质协调和控制损伤和修复的步骤。然而,随着时间的推移,衰老会降低干细胞的再生能力。在人的一生中,干细胞的数量会急剧减少,这可能是为什么愈合能力会随着年龄的增长而降低的原因。
摘要和保留意见
我们预计需要大量的时间和物质资源来成功地发展我们的抗衰老诊所业务。尽管成本可能会有很大的差异,这取决于我们在努力建立和推行抗衰老业务线时采用的业务模式,以及我们在推行此类计划时可能遇到的风险和挑战。与这类活动有关的费用一般预计包括下列方面的费用:雇用人员、确定地点和租赁或获取空间,包括实验室设施、办公空间、医疗设备和我们抗衰老诊所的其他费用、差旅、保险、合规和许可证相关费用以及法律费用。拥有和运营抗衰老诊所,或参与与诊所合作伙伴的合作安排,可能会产生其他成本,我们预计会产生与该业务相关的某些负债,其中一些可能是重大的。除其他费用外,我们可能需要为这些活动获得专门或补充保险,我们可能无法获得足够的保险,或者,如果我们可以获得,可能无法在我们可能希望开设抗衰老诊所的所有地区以优惠条件获得保险。
在我们能够获得必要资源并满足必要的适用监管要求的情况下,我们的目标是在近期内建立抗衰老诊所业务线(尽管目前由于各种因素的影响,这方面的时间框架仍不确定,如本“概述”部分和本代理声明/招股说明书的其他部分所述),目标是从中产生收入,我们打算将其用于扩大抗衰老诊所业务线并支持我们的其他发展努力,特别是我们进一步发展与我们的技术和能力相关的努力
206
环球RBC业务线。如果我们不能实现这一目标,我们可能无法及时开展与我们的通用RBC业务线相关的计划开发工作,如果我们能够在以后推进的话,我们可能会在我们的通用RBC业务线上面临更大的竞争。
除其他前提条件外,我们仍在分析可能适用于某些或所有业务活动的监管框架和合规要求,GIO管理层可能不时认为这些业务活动对在我们可能希望开展此类活动的地点建立和开展抗衰老诊所业务是有用或必要的。在一些司法管辖区,如果使用的干细胞是“成人自体”细胞,即来自成年人的干细胞,用于对同一个人进行治疗或治疗,或为同一个人的利益进行治疗或治疗,则干细胞治疗不需要经过严格的监管批准。此外,如果相关干细胞在被重新引入患者体内之前被“扩增”或增强,那么在相关的领域和程度上,不那么严格的监管框架往往不适用。此外,为了适用上述监管框架,对成人自体干细胞进行的任何程序都必须在提取干细胞的同一天进行,不保留或储存供以后或将来使用的样本。我们对监管和法律合规事项的评估,以及解释和遵守这些要求的努力,将是一个持续的过程,一些可能适用于我们希望在抗衰老诊所使用的部分或全部干细胞产品和疗法的法律和监管考虑因素正在改变,这可能会损害我们目前或未来推进建立、维持或扩大抗衰老诊所业务的计划的能力。
此外,在我们可能希望开设抗衰老诊所的一些司法管辖区,监管框架、许可证要求以及其他重要的法律和合规要求可能正在发生变化、不确定,并受到多种解释的影响。我们可能无法充分或完全保护自己免受部分或全部这些风险或与抗衰老诊所和诊所运营相关的其他风险和意外事件的影响,包括但不限于本代理声明/招股说明书中标题为“风险因素”的部分中描述的风险。今后,我们可能决定不开展本“概述”一节中所述的抗衰老诊所业务,或者,由于许多原因,包括ACIC或我们尚未确定或未知的原因,我们可能决定修改我们与抗衰老诊所有关的计划,可能会根据本“概述”一节中对此类业务的描述以及本代理声明/招股说明书中其他地方的描述进行重大修改。如果我们继续从事抗衰老诊所的业务,我们无法保证我们能够成功地做到这一点,我们也无法预测我们是否能够从我们与诊所合作伙伴建立和运营或开设的任何抗衰老诊所中获得收入或利润。如果我们追求抗衰老诊所的业务线,我们将面临来自现有业务和市场上可能出现的竞争对手业务的巨大竞争,我们可能无法区分我们的抗衰老诊所或通过任何抗衰老诊所提供抗衰老疗法或产品,这些抗衰老诊所在未来成为我们业务的一部分,使消费者或患者觉得有吸引力,或使我们能够在这一领域成功竞争,我们的经营结果可能会受到影响。
红细胞(通用红细胞)
概述
我们计划利用名为“生物反应器”的科学设备,开发大规模生产通用红细胞的能力,如下文所述。假设我们发展了生产通用红细胞的能力,我们计划争取FDA批准我们的通用红细胞,并在努力获得FDA批准的同时,向政府、医院、医疗服务提供商和其他潜在客户销售我们的通用红细胞在美国以外的地区(在可能允许销售和营销的司法管辖区)。
最终,我们相信我们的通用红细胞将成为人类捐献的“浓缩”红细胞(PRBCs)的可行替代品,后者是目前最常用的输血产品。目前,PRBCs是通过提取人类捐献的血液并用离心机分离出红细胞来制造的。一般来说,“全”血,或未被分离成不同细胞类型的血液,仅用于特定的医疗情况,即患者需要输入大量血液时。与全血相比,PRBCs不太可能导致输血相关的循环系统超负荷,因为改善血液氧携带能力和恢复血容量所需的血量较小。
市场机会和潜力:
2019年发表在《柳叶刀血液学杂志》上的一篇文章估计,全球每年的血液短缺约为1亿单位。血液疾病的日益流行,如罕见的遗传病、贫血、血液和造血器官紊乱引起的镰状细胞病,以及输血传染性感染和全球老年人口的不断增长,是推动献血市场的一些关键因素。此外,即使在
207
在可能提供献血的情况下,血液匹配要求昂贵和耗时,在无法极其仔细地储存、检查、处理和检测血液的情况下,疾病传播的风险相对较高。
这些因素加在一起,为我们的普遍皇家银行提供了一个看似强劲的市场机会,以满足或帮助缓解一个重大的全球健康问题。根据世界卫生组织(WHO)的数据,2018年全球采集了约1.18亿单位的血液,全球约7%的人口拥有通用献血者血型。
我们认为,我们的普遍皇家银行将:
| ● | 提出一种更具成本效益和无疾病的替代人类供体红细胞的方法; |
| ● | 帮助缩小现有献血者血液短缺的问题; |
| ● | 根据Strategic Market Research的数据,到2021年,全球输血市场价值将达到67亿美元,预计到2030年将增长到110亿美元以上,在这一市场中应对每年超过1亿个单位的市场机会(用于合并用途,包括解决全球约1亿个单位的短缺);以及 |
| ● | 具备在全球多个生产设施生产的能力,以满足全球需求。 |
全球血液短缺
全球献血市场目前面临下列挑战,其中包括:
供应不足:全世界每年约有1亿单位的血液供应不足。世卫组织估计,在大多数国家,献血率不到人口的1%。为了满足需求,献血率应在人口的1-3 %之间。除了缺乏足够的自愿捐献者之外,世界各地血液采集机构的短缺进一步加剧了人们的关切。
需求增加:由于全球人口老龄化,随着红细胞崩解率随年龄增长而显著增加,对血液的需求不断增加。例如,70至80岁的人的红细胞消耗量是20至40岁的人的8倍。此外,许多外科手术对血液供应系统的负担很大。例如,心脏直视手术平均需要六个单位的血液,而器官移植可能需要20多个单位的血液,而车祸受害者可能需要多达50个单位的血液。
安全性:许多国家的血液供应安全可能会受到影响,原因是病原体检测不足和采集的血液失活。目前,162个国家中有41个国家不能有效地筛查血液中的丙型肝炎、艾滋病毒、乙型肝炎和梅毒等不同疾病。此外,由于可能致命的人为错误,血液分型和其他病理血液检查可能是不正确的。
不相容:患者并非与所有血型都相容,并可能对某些血型产生不良反应。世界上只有7%的人口有通用献血者血型。
时机:由于时间限制,创伤情况往往不允许进行充分的血型分析。
文化和宗教障碍:许多人在文化和宗教上反对献血或从其他人类输血。
血液储存限制:红细胞可在冷藏条件下最多储存42天。血液供应的新鲜度决定了许多高风险手术的结果。
费用高:献血的总费用可高达每单位800至2500美元。因此,需要多单位献血的手术的血液成本可能非常昂贵。生产成本高仍然是所有其他生产红血球方法的主要障碍。目前生产红血球的方法可能成本过高,因此可能不是一个可行的经济选择。
208
然而,我们认为,我们的技术可能为大规模生产通用红细胞提供潜力,这可能为新鲜的、人类的、普遍接受的红细胞提供一个具有成本效益的选择。
我们的优势和策略
在多年的研究和开发中,我们的首席科学官Srivastava博士和他在GIOSTAR的团队开发了一个从干细胞产生和增殖我们的通用红细胞的过程。我们相信,GIOSTAR授权给我们的技术诀窍和商业秘密,包括但不限于斯里瓦斯塔瓦博士用来处理干细胞的技术、创建我们的通用红细胞的过程中的步骤,以及斯里瓦斯塔瓦博士在干细胞科学方面的丰富经验,使我们在这个领域具有竞争优势。我们相信,使用我们的技术生产的通用红细胞有潜力通过创造可用于任何人类患者的红细胞来改变目前献血系统的工作方式。由人类捐献的O阴性红细胞可以给予任何个体,无论血型如何。
我们相信,拥有基础知识和专有技术来创建我们的O阴性血型通用红细胞,使我们能够在改善当前供应链挑战和围绕血液需求的全球实践方面发挥潜在的巨大和关键作用。我们相信,我们的通用红细胞,一旦能够大规模生产,将是体外生产的O阴性红细胞的第一个市场,并将是无毒的,广泛适用,容易获得和成本效益。
一旦我们创建我们的通用红细胞的进程得到进一步发展和质量测试,我们将需要建立大规模制造我们的通用红细胞的途径。大规模生产红细胞需要使用一台或多台被称为“生物反应器”的机器,这些机器必须经过设计、建造和利用,才能生产出我们的通用红细胞。生物反应器是一种制造的设备或系统,它支持一个生物活跃的环境,除其他外,影响细胞的生长和分化。生物反应器的类型多种多样。我们期望使用一个生物反应器与一个封闭和自动化系统,能够制造我们的通用红细胞在无菌条件下临床使用。一般来说,生物反应器通过在受控环境下不断搅拌生物反应器内部的内容物来提供均匀的环境,以确保相同的温度、pH值和氧气水平,并提供营养物质和刺激的受控输送,从而对生产过程进行更多的控制。据我们所知,目前不存在生产红细胞所需类型的生物反应器,这很可能是因为设计、开发和制造这种生物反应器的高度技术性。我们预计,建造一个原型生物反应器以测试大规模生产我们的通用红细胞的能力将需要大量的时间和金钱,因为原型生物反应器将是为我们的目的定制的。我们目前没有能力或资源来创建或生产我们自己的原型生物反应器,并已开始与第三方制造商就构建原型生物反应器进行初步讨论,以测试我们的通用红细胞的生产。
一旦我们获得或建造了一个原型生物反应器,并且验证并优化了我们利用这种生物反应器大规模制造我们的通用红细胞的工艺和程序,我们计划向FDA提交一份用于生产和使用我们的通用红细胞的研究新药(“IND”)申请。我们认为,我们的普遍红细胞可用于应对重大的市场挑战,下文将对此进行更详细的讨论。如果得到FDA的开发和批准,并通过其他司法管辖区的相关监管程序(如适用),我们计划向多个行业的各种买家推销我们的通用红细胞,包括医院、第一反应组织、政府、军队、研究机构和其他可能需要我们的通用红细胞的组织。此外,如果我们得到FDA的批准,我们将考虑推行联邦医疗保险和私人保险,以便我们的通用红细胞可能有资格获得保险补偿。
无论我们是否寻求FDA的批准,我们都计划在美国以外的司法管辖区销售我们的通用RBC,这些司法管辖区目前或将来可能被允许销售,但在所有情况下都要遵守适用的法律和监管要求。我们一开始可能会把注意力集中在那些由于目前献血不足而对红细胞有迫切需求的地区。调查产品在美国境外的出口须遵守接受国的监管要求以及《联邦食品药品和化妆品法》规定的美国出口要求。有关更多信息,请参见下文的“政府规章——出口要求”。
RBCs----工艺和生产
GIOSTAR建立了人类胚胎干细胞(hES)培养物,以产生hES细胞,然后进行免疫染色,即对细胞进行染色以鉴定某些特性,以鉴定八聚体结合转录因子4(Oct4),这是一种参与未分化干细胞自我更新的关键蛋白质。Oct4经常被用作标记
209
未分化的干细胞来评估干细胞的“多能性”,即在体内发育成多种不同类型细胞或组织的能力。
hES细胞受免疫染色显示Oct4,一种多能性标志物
资料来源:GIOSTAR
在hES细胞的多能性被证实后,hES细胞被转移到一个不粘附的容器中。为了促进hES细胞的类胚体(EB)的形成,这些细胞是多能干细胞的三维聚集体(相对于单层培养),使干细胞的产量高于单层培养,这些细胞在专门用于促进EB形成的培养基中培养24小时。
24小时后,培养基被专门设计用于引导hES细胞产生红细胞的培养基取代。然后对hES细胞进行免疫染色以检测CD34,CD34是一种由CD34基因编码的蛋白质,通常用于识别造血干细胞/祖细胞的存在,这是一种未成熟的干细胞,能够发育成所有类型的血细胞,包括白细胞、血小板和红细胞。

(1)EB的形成,(2)表达CD34抗体的细胞,藻红蛋白染色;(3)来自hES细胞的细胞。棕色显示了CD34的表达。
资料来源:GIOSTAR
一旦造血干细胞/祖细胞的存在得到确认,培养基就会再次被改变,并被一种红细胞分化培养基(“EDM”)取代,这种培养基是一种专门设计用于帮助干细胞发育成红细胞而不是另一种血细胞的培养基。我们所说的“前红细胞”,也就是可以最终发育成红细胞的干细胞,其特征是通过Wright-Giemsa染色完成的,Wright-Giemsa染色是一种用于外周血涂片和骨髓标本的经典血膜染色剂。如下图所示,前红细胞通常由一个大的细胞核的存在来证明。
210
10倍放大20倍放大

Giemsa染色显示前红细胞显示大细胞核
资料来源:GIOSTAR
前红细胞最终扩张并发展成红细胞。为了检测成熟红细胞的存在,对红细胞进行Wright-Giemsa染色。红细胞通常形状像一个没有细胞核的双凹盘,或一个甜甜圈。
20倍放大
红细胞显微镜观察
资料来源:GIOSTAR
使用我们的许可技术的红细胞增殖数据是有希望的,我们相信我们的过程导致的增殖率显著高于其他现有技术,如成纤维细胞饲养器或基于骨髓的饲养器。我们将继续优化创建我们的通用红细胞的过程,为测试使用原型生物反应器生产红细胞的能力做好准备。
加州大学许可协议;Heamgen专利权
我们实施我们的专有技术以及创建和潜在利用本“概述”部分所述的通用RBC的能力可能取决于某些专利权,这些专利权是根据与加州大学校董(“加州大学”)于2013年6月28日签订的许可协议(“Heamgen许可协议”)独家授权给我们的管理人员控制的实体Heamgen Inc.(“Heamgen”)拥有的。获得许可
211
专利权涵盖生产人类红细胞干细胞的特定过程和方法,我们可能会在开发和最终大规模生产我们的通用红细胞的计划中使用这些过程和方法。Patel先生和Srivastava博士已同意促使Heamgen在完成业务合并之前根据Heamgen许可协议向我们授予Heamgen的独家分许可。
Heamgen许可协议授予Heamgen在某些“专利权”下的独家许可,以制造、制造、使用、使用、销售、销售、要约销售和进口以及在开发和销售人类血液替代品领域进口“许可产品”和实践“许可方法”,不包括作为非临床研究试剂销售,在世界各地均有专利权。“专利权”为美国专利申请号61/265,4861对于“制造和使用骨髓间充质干细胞和红细胞祖细胞的组合物和方法”及其持续应用,包括部分分割、替换和延续(仅限于其权利要求在说明书中得到完全支持并有权在专利申请的优先日期),就上述应用发布的任何专利,包括重新发布、复审和延期,以及相应的外国申请或专利。在Heamgen许可协议中,“许可产品”被定义为专利权中声称的或通过许可方法生产的任何服务、组合物或产品,或其制造、使用、销售、要约销售或进口如果没有许可授予,将构成对专利权内任何未决或已发布的权利要求的侵权、诱导侵权或共同侵权。“许可方法”是指专利权中主张的任何方法,如果没有许可,使用该方法将构成对专利权中任何未决或已发布的权利主张的侵权、诱导侵权或共同侵权。
Heamgen许可协议允许将许可权,包括行使专利权的权利,转授给第三方,只要许可是排他性的和某些其他条件。Heamgen许可协议的任何转让都需要得到加州大学的同意。在业务合并之前,我们将与Heamgen签订分许可协议,根据该协议,我们将能够根据Heamgen许可协议的条款使用专利权。Heamgen许可协议要求Heamgen向加州大学支付一定的许可维护费和里程碑付款,并向加州大学提供购买Heamgen未来提供的任何股本证券的至多5%的权利,以及相当于任何许可产品净销售额4%的特许权使用费或Heamgen收到的部分分许可使用费。我们预计Heamgen可能会要求我们贡献一部分许可维持费、里程碑付款和特许权使用费(包括从商业销售开始的某些最低年度特许权使用费),以履行Heamgen根据与加州大学签订的Heamgen许可协议所承担的义务,除非Heamgen许可协议被修改或加州大学同意根据Heamgen许可协议的条款放弃这些权利,如果我们成功地利用专利权开发和商业化我们的通用RBC或任何其他产品或服务,我们可能有义务根据Heamgen许可协议的条款,在Heamgen许可协议的期限内向加州大学支付此类维护费、里程碑付款和特许权使用费。
Heamgen许可协议的期限将持续到专利权最后到期,除非根据其条款提前终止。我们预计获得专利权和使用专利权的权利可能对我们开发和利用我们的红细胞相关技术和专有技术以创建我们的通用红细胞的能力具有重要意义,并且我们根据Heamgen许可协议获得Heamgen权利的任何损失或减少可能会严重延迟、损害或使我们无法以本“概述”中描述的方式开发和发展我们的通用红细胞业务线的能力。
摘要和保留意见
我们认为,一旦我们发展能力,大规模生产我们的通用红细胞,这些通用红细胞就有潜力在世界各地得到利用,以解决献血者血液短缺问题。我们计划的Universal RBC业务线的成功,以及我们是否有能力推行某些或任何必要的战略和关键要素,以便将我们现有的专门知识和能力打造成Universal RBC业务线,从而使我们成功地将Universal RBC商业化,取决于许多已知和未知的因素和意外情况,包括但不限于我们使用生物反应器优化生产过程的能力,我们是否获得FDA的批准,以及我们与美国以外司法管辖区的客户联系的结果。如上文和本代理声明/招股说明书的其他部分所述,我们对通用RBC业务线计划中的活动和战略要素的追求将需要获得大量资金、高素质的人员、实验室和其他设施和设备,并且很可能需要与第三方进行业务合作。我们目前无法获得其中任何一项,或者,就我们确实能够获得其中一些重要要求而言,这种机会目前是有限的。我们不能保证,我们将能够成功地发展和发展我们目前的能力和专门知识,使之成为一个红血球业务线,或满足我们的通用红血球或红血球相关技术和专门知识产生收入的部分或全部必要条件。
1美国专利第7,703,487号主张该临时申请的优先权,并根据Heamgen许可协议获得许可。
212
Active化妆品公司
概览–策略/业务项目计划
现在科学界已经很好地认识到,干细胞的再生能力在于干细胞分泌的小信号分子。此外,干细胞分泌许多生长因子、抗炎细胞因子、胶原蛋白等因子,以及能够改善皮肤血管形成和潜在改善炎症损伤细胞愈合过程的因子,这些因子使干细胞成为我们活性化妆品业务线中的一种有效的活性成分。“活性”化妆品指的是含有活性成分、可长期(而非短期)改善皮肤或头发健康的产品。
Srivastava博士和他在GIOSTAR的团队开发了在实验室环境中收集成人干细胞分泌的信号分子的权利和诀窍,并就成人干细胞衍生分子在受损和退化皮肤上的最佳功效浓度的过程进行了标准化,并开发了配方,旨在用于局部或美容用途的产品。我们相信,GIOSTAR授权给我们的技术诀窍和商业秘密,包括但不限于收集干细胞分子的过程、斯里瓦斯塔瓦博士的干细胞研究经验和处理干细胞分子的过程,以及干细胞分子与之结合以产生AHSDM的培养基配方,为我们提供了在未来将AHSDM商业化的技能和知识。“AHSDMs”指的是GIOSTAR的培养基中含有高浓度的成人干细胞衍生分子,我们预计这种培养基会作为一种产品进一步开发并最终商业化,我们相信这种产品可以融入其他化妆品产品中。利用这一技术专长和专门知识,GIOSTAR公司最近开始试制各种含有AHSDM的血清、乳膏和喷雾剂。
根据合并协议的条款,在拟议的业务合并完成之前,GIOSTAR和GIO将签订GIOSTAR供应协议,根据该协议,GIOSTAR将在完成合并后及之后的四年期间,按照在执行合并协议时商定的条款向GIO供应AHSDM的数量,并授予我们销售AHSDM的许可,如下文“GIOSTAR供应协议”标题下所述。AHSDMs可能不是我们期望作为Active Cosmetics业务线的一部分销售的唯一产品,但它可能是我们最初的开发和商业化努力的重点,但在适用的范围内满足任何监管要求。
我们预计最初将专注于建立我们的活性化妆品业务线的两个主要战略。我们的第一个策略是向其他参与开发、制造或销售化妆品产品的公司出售AHSDM,以便将AHSDM作为一种活性成分纳入其他化妆品产品。我们可能会与我们的AHSDM的买家达成各种安排,包括但不限于某些法域的惯常分销关系、最低承诺合同和独家供应商合同,尽管目前不存在此类安排、关系或合同协议。我们相信,根据我们管理团队的一个附属公司以前生产的试用量,AHSDM可以被纳入一系列旨在帮助改善皮肤血管化的护肤品中,并试图帮助炎症损伤细胞的愈合过程。
未来,我们也可能开发我们自己的护肤品系列,专注于以下领域的产品:(i)面部抗皱精华液,(ii)日间护肤霜,(iii)眼部抗皱精华液,(iv)高端护肤霜和(v)头发活力配方。我们设想通过各种渠道进行销售,除了批发和零售分销渠道外,还可能包括在我们的抗衰老诊所、在线分销和电视网络。我们也可能寻求战略伙伴关系,以帮助简化产品品牌和分销。
机会和潜力
根据Grandview Research的数据,目前抗衰老化妆品的市场规模约为1300亿美元,根据Freelance Formulations的数据,潜在的营业利润率为65%至75%。随着更年轻的消费者进入市场,该市场也在继续增长,他们更多的是护肤品,而不是老年消费者。我们计划利用这个不断增长的市场,无论是通过向成熟的化妆品企业出售AHSDM,还是通过开发我们自己的活性化妆品产品。
GIOSTAR供应协议
在交易结束时,我们将与GIOSTAR签订GIOSTAR供应协议,根据该协议,GIOSTAR将向我们提供AHSDM。根据GIOSTAR供应协议的条款,GIOSTAR同意以GIOSTAR的单位直接可变成本,加上合理的自付费用交付成本,向我们和我们的子公司供应AHSDM。紧随其后
213
交易结束后,GIOSTAR将向我们提供AHSDM,总成本基础为500,000美元,交易结束后的总成本基础价值将从交易结束一周年的1,000,000美元增加到交易结束后第二、三和四周年的2,000,000美元、4,000,000美元和6,000,000美元。
根据GIOSTAR供应协议的条款,GIOSTAR还将同意按照其当前的产品规格生产AHSDM,授予我们分销和销售AHSDM的独家许可,并且,鉴于参与该安排的相关方,我们已同意我们的独立董事将代表GIO根据GIOSTAR供应协议做出所有决定和采取所有行动。
摘要和保留意见
虽然我们有计划将积极化妆品作为一个业务线,但我们尚未开始与这一业务线有关的业务。迄今为止,我们尚未在市场上销售任何AHSDM,或通过科学研究证实“活性成分”可以成功地融入化妆品或其他美容或抗衰老产品(或者,如果“活性成分”可以融入其中,试验或测试是否会证明功效,或者AHSDM是否达到了预期目的,无论是独立销售还是融入任何其他产品)。从监管的角度来看,我们仍在评估与化妆品产品和干细胞产品的制造、分销、广告和销售有关的监管框架和适用要求,我们可能希望在这些地区销售我们的活性化妆品产品和/或我们的AHSDM,以及GIOSTAR未来向我们提供的AHSDM的数量。如果由于任何原因,我们不能销售AHSDM,或无法开发其他配方或化妆品产品,我们可以销售给第三方,或直接销售给市场上的消费者,在这些市场中,我们预计会建立我们的活性化妆品业务线,我们从我们计划的活性化妆品业务线产生收入的能力可能会受到影响,我们可能会决定不继续从事这一业务线,或限制我们在这一业务线投入的资源,根据GIOSTAR供应协议,我们收到的任何AHSDMS可能不具备GIO管理层期望的价值。
在业务合并完成之前,我们将无法从GIOSTAR获得AHSDM;此外,我们目前无法获得资源,包括人员、实验室空间、原材料和生产Active Cosmetics产品所需的其他组件,或其内部组件,包括AHSDM。此外,我们无法向投资者保证,我们根据GIOSTAR供应协议预期收到的AHSDM数量实际上将提供给我们,或者,如果提供给我们,我们将成功地将AHSDM出售给第三方(作为独立产品或作为将并入其他化妆品产品的产品)。如果AHSDMs不能出售给第三方,或者如果出售给第三方,但这些第三方发现AHSDMs不能成功地整合到他们正在开发、分销、销售或营销的化妆品产品中(如适用),或者AHSDMs能够融入的产品(如果有)不能证明其相对于其预期目的的功效,或者由于任何其他原因,在市场上不具有竞争力,那么GIO认为AHSDMs尤其存在的市场,而AHSDMS通常不存在许多市场,或者可能比GIO管理层认为的更有限。此外,正如下文进一步描述的那样,活性化妆品和一般化妆品市场竞争激烈,与我们更知名、资本充足的竞争对手相比,我们可能很难成功地为我们的产品创造需求,其中许多竞争对手已经享有品牌或知名度,并拥有我们目前没有的客户基础和行业关系。
新冠疫情治疗
干细胞疗法已被证明有助于缓解由感染严重急性呼吸综合征冠状病毒2(SARS-CoV-2)(简称“新冠疫情”)的人类所引起的极端炎症。由于新冠疫情的蔓延,世界卫生组织随后将新冠疫情列为国际关注的突发公共卫生事件,并宣布为全球大流行病级别。
2020年4月,GIOSTAR在扩大使用范围(也称为同情使用)下,获得FDA授权,可紧急使用干细胞疗法治疗被诊断为新冠疫情的住院患者的肺部急性炎症。这一富有同情心的使用授权使GIOSTAR能够在个案基础上提供干细胞治疗,并需要获得医生、GIOSTAR医疗主管和FDA的授权。GIOSTAR授权我们获得FDA授权的GIOSTAR新冠疫情治疗的权利,其中包括干细胞的静脉输注。我们目前没有使用,我们目前也不期望在这个时候使用新冠疫情治疗方案,但是,我们将来可能会重新研究这项技术,或使用这种技术来协助将来进一步开发其他治疗方法。
214
公司历史和Structure
我们于2021年9月20日根据英格兰和威尔士的法律成立为一家私营公司。2021年5月,我们成立了全资子公司GOVCOV LTD(新冠疫情),2021年10月,我们成立了其他全资子公司GIOBLOOD LTD(环球红细胞)、GIO HEALTH LTD(抗衰老诊所)和GIOGI LTD(活性化妆品),作为英格兰和威尔士法律下的私营公司。
交割后,我们将成为GIO World Health Holdings,Inc.的全资子公司,拥有四家运营子公司,如上文所述,每一家子公司都将根据GIOSTAR许可协议获得与业务线相关的某些权利的分许可:

政府条例
世界各国对干细胞疗法和产品的监管不同,有些国家允许使用其他法域禁止的干细胞疗法和产品。我们计划持续监测和分析干细胞领域的监管变化,以确保我们遵守适用的法律法规。
与我们的抗衰老诊所有关的规例
我们的抗衰老诊所对治疗的监管因司法管辖区的不同而有很大差异。目前,美国FDA批准使用的唯一基于干细胞的产品包括从脐血中提取的造血干细胞(造血祖细胞)。这些产品被批准用于患有与血液生产有关的影响身体系统的疾病的患者。
美国以外的许多司法管辖区,包括欧盟,都需要获得适用的干细胞治疗监管机构的批准。然而,提供干细胞治疗的非法性的一个关键例外是,在许多司法管辖区,比如美国,在满足特定标准的情况下,可以提供某些服务。例如,在美国,《联邦法规》(CFR)第1271部分第21条规定了人体细胞、组织或基于细胞或组织的产品(HCT/Ps)的制造,其中规定了允许在未获得FDA上市前授权的情况下使用HCT/Ps的标准。这些标准包括,使用的干细胞必须是成体自体细胞,这些细胞在被放回人体之前不能以任何方式“扩增”或增强,而且任何使用成体自体干细胞的程序都必须在捐献干细胞的同一天进行。不能保留样品以备日后使用。只要提供者符合21 CFR 1271中的严格要求,干细胞疗法是法律“允许的”,尽管它们没有得到FDA的“批准”。
目前,美国以外的许多司法管辖区都有类似于上面讨论的21 CFR 1271的要求,但要求较少的监管互动和成本,以确保干细胞疗法被允许。然而,监管要求可能会迅速改变。干细胞尤其受到不同的文化、伦理和宗教观点的影响,可能影响监管。我们计划持续监测和分析我们预期针对抗衰老诊所的司法管辖区的监管要求,以确保我们遵守当地法规。
与我们的普遍RBC和追求监管批准相关的法规
美国食品药品监督管理局(FDA)以及联邦、州和地方各级以及外国的其他监管机构,广泛地监管研究、开发、测试、制造、质量控制、进口,
215
出口,安全,有效性,标签,包装,储存,分配,记录保存,批准,广告,促销,营销,取样后批准监测和批准后报告生物制剂,如我们正在开发的。在我们的产品在美国合法销售之前,我们可能会寻求FDA的批准,在这些国家合法销售之前,我们可能会寻求适当的外国监管机构的批准。一般来说,我们在其他国家的活动将受到性质和范围与美国相似的监管,尽管可能存在重大差异。
美国和欧盟以外的政府监管。
我们将受制于其他司法管辖区的各种监管规定,其中包括临床研究以及我们产品的任何商业销售和分销。由于生物来源的原材料具有独特的污染风险,在一些国家,其使用可能受到限制。目前,我们正在评估美国和欧盟以外司法管辖区的监管制度,以确定如果我们成功地生产了我们的通用红细胞,我们将能够在获得FDA批准的同时在哪里销售它们。
美国法规
生物开发过程
在美国,生物制品受《联邦食品、药品和化妆品法》、《公共卫生服务法》以及其他联邦、州、地方和外国法规及其实施条例的监管。除非获得FDA的批准,否则我们将无法在美国销售我们的通用红细胞。获得监管批准以及随后遵守适当的联邦、州、地方和外国法规和条例的过程需要花费大量的时间和财政资源。FDA要求的生物制剂在美国上市前的流程通常涉及以下方面:
| ● | 完成按照FDA的良好实验室规范要求进行的临床前实验室测试和动物研究; |
| ● | 向FDA提交IND,必须在临床试验开始前生效; |
| ● | 在试验开始前,由每个临床地点的机构审查委员会、IRB或伦理委员会批准; |
| ● | 根据FDA通常被称为良好临床实践或GCP的规定进行充分且控制良好的人体临床试验,以及保护人体研究对象及其健康信息的任何附加要求,以确定拟议生物产品候选者达到其预期目的的安全性、纯度和效力; |
| ● | 在完成所有关键临床试验后,准备并向FDA提交生物制品许可申请(BLA); |
| ● | 满意地完成FDA咨询委员会的审查(如适用); |
| ● | FDA在收到BLA后60天内决定提交审查申请; |
| ● | 满意地完成对生产拟议产品的生产设施或设施的FDA批准前检查,以评估符合cGMP的情况,并确保设施、方法和控制措施足以保持生物产品的持续安全性、纯度和效力,并在适用的情况下评估符合FDA当前的良好组织规范(cGTP)、使用人体细胞和组织产品的要求,以及评估符合GCP的选定临床调查地点; |
| ● | FDA可能对产生支持BLA数据的非临床和临床研究站点进行审计;以及 |
| ● | FDA审查并批准BLA,以允许该产品在美国用于特定适应症的商业营销。 |
216
在人体测试任何候选生物产品之前,候选产品进入临床前测试阶段。临床前试验,也称为非临床研究,包括对产品化学、毒性和配方的实验室评估,以及动物研究,以评估候选产品的潜在安全性和活性。临床前试验的进行必须符合联邦法规和要求,包括GLPs。
在美国开始第一个候选产品的临床试验之前,我们需要向FDA提交IND。IND是向FDA申请授权,以将一种研究性新药用于人类。IND提交的中心重点是一般研究计划和临床研究方案。有些临床前试验可能会继续,甚至在提交IND之后。该IND还包括动物和体外研究的结果,评估产品的毒理学、药代动力学、药理学和药效学特征;化学、制造和控制信息;以及支持使用研究产品的任何可用的人类数据或文献。在人体临床试验开始之前,IND必须变得有效。IND在FDA收到30天后自动生效,除非FDA在30天期限内对拟议的临床试验提出安全问题或疑问。在这种情况下,IND可能会被暂停临床试验,并且IND赞助商和FDA必须在临床试验开始之前解决任何悬而未决的问题或问题。因此,提交IND可能会或可能不会导致FDA授权开始临床试验。
除了在美国启动临床试验之前向FDA提交IND之外,某些涉及重组或合成核酸分子的人体临床试验也受到机构生物安全委员会(IBCs)的监督,如美国国立卫生研究院(National Institutes of Health)或NIH(NIH)、《关于重组DNA分子的研究指南》(Guidelines for Research Involving Recombinant DNA Molecules)或《NIH Guidelines》(NIH Guidelines)所规定的那样。IBC评估研究的安全性,并确定对公众健康或环境的任何潜在风险,这种审查可能会导致临床试验开始前的一些延迟。尽管NIH指南不是强制性的,除非相关研究是在接受NIH资助的重组或合成核酸分子研究的机构进行或赞助的,但许多公司和其他不受NIH指南约束的机构自愿遵循这些指南。
临床试验涉及在合格调查人员的监督下,按照GCPs向人类受试者施用研究产品,其中包括要求所有研究受试者就其参与任何临床研究提供知情同意。临床试验是根据方案进行的,除其他事项外,详细说明了研究的目标、用于监测安全性的参数和要评估的有效性标准。在产品开发期间进行的每一项连续临床试验以及任何后续的方案修订都必须向现有的IND提交一份单独的呈件。此外,每个提议进行临床试验的地点的独立IRB必须在该地点开始临床试验之前审查和批准任何临床试验的计划及其知情同意书,并且必须监测研究直至完成。IRB负责保护试验参与者的福利和权利,并考虑诸如参与临床试验的个人所面临的风险是否被最小化以及相对于预期收益是否合理等项目。IRB还批准必须提供给每个临床试验对象或其法律代表的知情同意书,并且必须监督临床试验直至完成。监管当局、IRB或赞助者可随时以各种理由暂停临床试验,包括发现受试者面临不可接受的健康风险或试验不太可能达到其规定的目标。一些研究还包括由临床研究赞助者组织的一个由合格专家组成的独立小组进行监督,该小组被称为数据安全监测委员会,该委员会根据获得研究的某些数据,授权一项研究是否可以在指定的检查点继续进行,如果确定受试者存在不可接受的安全风险或其他理由(例如没有证明疗效),可能会暂停临床试验。对向公共登记处报告正在进行的临床研究和临床研究结果也有规定。
就BLA批准而言,人体临床试验通常分三个可能重叠或合并的连续阶段进行:
| ● | 第1阶段——研究产品最初被引入健康的人类受试者或患有目标疾病或病症的患者。这些研究旨在测试研究产品在人体中的安全性、剂量耐受性、吸收、代谢和分布、与增加剂量相关的副作用,并在可能的情况下获得有效性的早期证据。对于某些用于治疗严重或危及生命的疾病,如癌症的产品,特别是当产品本身毒性太大而无法合乎道德地给予健康志愿者时,通常在患者中进行初步人体测试。 |
| ● | 第2阶段——研究产品用于有特定疾病或状况的有限患者群体,以评估初步疗效、最佳剂量、剂量耐受性和给药时间表,并确定可能的不良副作用和安全风险。在开始规模更大、成本更高的3期临床试验之前,可能会进行多个2期临床试验以获取信息。 |
217
| ● | 第3阶段——研究产品用于扩大的患者群体,以进一步评估剂量,提供具有统计学意义的临床疗效证据,并进一步测试安全性,一般是在多个地理上分散的临床试验地点。这些临床试验旨在确定研究产品的总体风险/收益比率,并为产品批准提供充分的基础。通常,FDA需要进行两个充分且控制良好的3期临床试验,才能批准BLA。 |
在某些情况下,FDA可能会要求或公司在产品获得批准后自愿进行额外的临床试验,以便在预期的治疗适应症中获得有关该产品的更多信息,特别是在长期安全性随访方面。完成这些所谓的第4阶段研究也可能成为批准BLA的一个条件。
在进行临床试验的同时,公司可以完成更多的动物研究,开发有关候选产品生物学特性的更多信息,并且必须按照cGMP要求最终确定以商业数量生产该产品的过程。制造过程必须能够始终如一地生产候选产品的高质量批次,并且除其他外,必须开发测试最终产品的安全性、纯度和效力的方法。此外,必须选择和测试适当的包装,并且必须进行稳定性研究,以证明候选产品在其保质期内没有发生不可接受的变质。
FDA提交和审查BLA
假设按照所有适用的监管要求成功完成所有必要的测试,产品开发、非临床研究和临床试验的结果将作为BLA的一部分提交给FDA,请求批准该产品用于一个或多个适应症的市场营销。BLA必须包括从临床前和临床研究中获得的所有相关数据,包括阴性或模棱两可的结果以及阳性结果,以及与产品的化学、制造、控制和拟议标签等相关的详细信息。数据可以来自公司赞助的旨在测试使用该产品的安全性和有效性的临床研究,也可以来自多种替代来源,包括由独立调查人员发起的研究。为了支持上市批准,提交的数据必须在质量和数量上足够,以确定研究药物产品的安全性和有效性,使FDA满意。提交BLA需要向FDA支付大量的应用程序使用费,除非适用豁免或豁免。
在提交申请后的60天内,FDA对提交的BLA进行审查,以确定其是否基本完整,然后FDA才接受提交申请。FDA可以拒绝提交它认为不完整或在提交时不能适当审查的任何BLA,并可以要求提供更多信息。在这种情况下,BLA必须与附加信息一起重新提交。重新提交的申请在FDA接受申请之前也要接受审查。
一旦BLA被接受提交,FDA的目标是在提交日期后的十个月内对标准申请进行审查,如果申请符合优先审查的条件,则在FDA接受提交申请后的六个月内进行审查。在标准审评和优先审评中,审评过程也可能因FDA要求提供更多信息或澄清而延长。FDA对BLA进行审查,以确定产品是否安全、纯净、有效,以及产品的制造、加工、包装或保存设施是否符合旨在确保产品持续安全、纯净和有效的标准。FDA还可能召集一个咨询委员会,就申请审查问题提供临床见解。咨询委员会是由包括临床医生和其他科学专家在内的独立专家组成的小组,负责审查、评估申请是否应得到批准以及在何种条件下提出建议。FDA不受咨询委员会建议的约束,但在做出决定时会仔细考虑这些建议。
在批准BLA之前,FDA通常会检查生产该产品的一个或多个设施。FDA不会批准申请,除非它确定生产工艺和设施符合cGMP,并且足以确保产品在要求的规格范围内的一致生产。对于同时也是人类细胞或组织产品的候选产品,如果制造商不遵守cGTP,FDA也不会批准该申请。这些是FDA的法规,管理用于制造人体细胞、组织、细胞和组织制品或HCT/Ps的方法以及设施和控制,HCT/Ps是用于植入、移植、输液或转移到人体受体的人体细胞或组织。GTP要求的主要目的是确保以细胞和组织为基础的产品的制造方式旨在防止传染病的传入、传播和传播。FDA的规定还要求组织机构在FDA登记和列出其HCT/Ps,并在适用时通过筛选和测试对捐赠者进行评估。此外,在批准BLA之前,FDA通常会检查一个或多个临床站点,以确保符合GCP。如果FDA确定申请、制造过程或制造设施不可接受,它将在提交的文件中概述缺陷,并经常要求提供额外的测试或信息。尽管如此
218
提交任何所要求的额外信息,FDA最终可能决定该申请不满足批准的监管标准。
在FDA对BLA进行评估并对将生产研究产品和/或其药物的生产设施进行检查后,FDA可能会发出批准函或完整回复函或CRL。批准书授权该产品的商业营销,并附有针对特定适应症的特定处方信息。CRL表明申请的审查周期已经完成,不会以目前的形式批准申请。CRL将描述FDA在BLA中发现的所有缺陷,除非FDA确定支持申请的数据不足以支持批准,FDA可以发布CRL,而无需首先进行必要的检查、测试提交的产品批次和/或审查提议的标签。在发布CRL时,FDA可能会建议申请人为使BLA处于批准状态而可能采取的行动,包括要求提供更多信息或澄清。如果适用的监管标准未得到满足,需要额外的测试或信息和/或需要上市后的测试和监督以监测产品的安全性或有效性,FDA可能会延迟或拒绝批准BLA。如果签发了CRL,担保人必须重新提交BLA,解决信函中指出的所有缺陷,或撤回申请。即使提交了这类数据和信息,FDA也可以判定BLA不符合批准标准。
如果某一产品获得了监管批准,这种批准将被授予特定的适应症,并可能导致对该产品可能用于市场销售的指定用途的限制。例如,FDA可能会批准带有风险评估和缓解策略的BLA,以确保产品的益处大于其风险,或以其他方式限制任何批准的范围。REMS是一种安全策略,旨在管理与产品相关的已知或潜在的严重风险,并通过管理其安全使用,使患者能够继续获得此类药物,并可能包括药物指南、医生沟通计划或确保安全使用的要素,例如限制分配方法、患者登记和其他风险最小化工具。除其他事项外,FDA还可能以更改提议的标签或制定适当的控制和规格为批准条件。一旦获得批准,如果未能遵守上市前和上市后的要求,或者产品进入市场后出现问题,FDA可能会撤回对产品的批准。FDA可能要求进行一项或多项第4期上市后研究和监督,以进一步评估和监测产品商业化后的安全性和有效性,并可能根据这些上市后研究的结果限制产品的进一步营销。
加速发展和审查方案
FDA为合格的候选产品提供了一系列快速开发和审查计划。例如,如果新的生物产品旨在治疗严重或危及生命的疾病或病症,并证明有可能解决该疾病或病症未得到满足的医疗需求,则有资格获得快速通道指定。快速通道指定适用于产品和正在研究的具体指示的组合。新生物制剂的发起人可以在产品临床开发期间的任何时候要求FDA指定该生物制剂为快速通道产品。快速通道产品的赞助者有机会在产品开发期间与适用的FDA审查小组进行更频繁的互动,一旦提交了BLA,候选产品可能有资格获得优先审查。快速通道产品也可能有资格进行滚动审查,在提交完整的申请之前,FDA可以考虑在滚动的基础上对BLA的部分进行审查,如果申办者提供了提交BLA各部分的时间表,FDA同意接受BLA各部分,并确定该时间表是可以接受的,申办者在提交BLA第一部分时支付任何必要的使用费。
旨在治疗严重或危及生命的疾病或病症的候选产品也可能有资格获得突破性疗法认定,以加快其开发和审评。如果初步临床证据表明,候选产品单独或与一种或多种其他药物或生物制剂联合使用,可能在一个或多个具有临床意义的终点(例如在临床开发早期观察到的实质性治疗效果)上显示出比现有疗法有显著改善,则候选产品可以获得突破性疗法认定。该称号包括所有快速通道项目的特点,以及最早从第一阶段开始的更密集的FDA互动和指导,以及加快产品候选者的开发和审查的组织承诺,包括高级管理人员的参与。
提交给FDA批准的任何生物制剂上市申请,包括具有快速通道指定和/或突破性疗法指定的候选产品,可能有资格获得旨在加速开发和审查的其他类型的FDA项目,例如优先审查和加速批准。如果产品候选者有可能提供安全和有效的治疗,而不存在令人满意的替代疗法,或与已上市产品相比,在治疗、诊断或预防疾病方面有显着改善,则该产品候选者有资格获得优先审评。FDA将努力将额外资源用于评估指定优先审评的新生物制品的申请,以促进审评。为
219
最初的BLA,即优先审评认定,意味着FDA的目标是在60天申报日期后的六个月内对上市申请采取行动(而标准审评为十个月)。
此外,考虑到病情的严重性、罕见性或普遍性,以及替代疗法的可获得性或缺乏性,对治疗严重或危及生命的疾病或病症的安全性和有效性进行研究的候选产品,一旦确定该产品对合理可能预测临床获益的替代终点有影响,或对可在不可逆发病率或死亡率之前测量的临床终点有合理可能预测对不可逆发病率或死亡率或其他临床获益的影响,可能会获得加速批准。作为加速批准的一个条件,FDA通常会要求申办者进行充分且控制良好的上市后临床研究,以验证和描述对不可逆的发病率或死亡率或其他临床益处的预期影响。如果申办者未能进行所需的上市后研究,或此类研究未能验证预期的临床益处,则获得加速批准的产品可能会被加速撤回程序。此外,对于正在考虑加速批准的产品,除非FDA另行通知,FDA一般要求,所有打算在上市批准后120天内传播或发布的广告和宣传材料都应在批准前提交给FDA进行审查。
2017年,FDA设立了一项新的再生医学先进疗法,即RMAT,旨在促进符合以下标准的任何生物制剂的有效开发计划,并加快其审查:(i)该生物制剂符合RMAT的定义,即细胞疗法、治疗性组织工程产品、人类细胞和组织产品,或使用此类疗法或产品的任何组合产品,只有有限的例外;(ii)该生物制剂旨在治疗、改变、逆转,或治愈严重或危及生命的疾病或病症;及(iii)初步临床证据显示该生物制剂有潜力解决此类疾病或病症未获满足的医疗需求。RMAT指定提供了突破性疗法指定的所有好处,包括更频繁地与FDA会面,讨论候选产品的开发计划以及滚动审评和优先审评的资格。获得RMAT指定的候选产品也可能有资格根据合理可能预测长期临床益处的替代或中间终点获得加速批准,或依赖从大量临床试验地点获得的数据,包括通过将试验扩大到其他地点。获得加速批准的RMAT指定产品可酌情通过提交临床证据、临床研究、患者登记或其他真实世界证据来源(如电子健康记录)、通过收集更大的确证数据集、或通过批准后监测所有接受此种疗法的患者在此种疗法获得批准之前满足其批准后的要求。
快速通道指定、突破性疗法指定、优先审评、加速批准和RMAT指定不会改变批准标准,但可能会加快开发或批准过程。即使一个候选产品有资格参加其中一个或多个项目,FDA也可能在以后决定该产品不再符合资格条件,或者决定FDA审查或批准的时间不会缩短。
核准后要求
生物制剂受到FDA的普遍和持续监管,其中包括与记录保存、不良经历报告、定期报告、产品抽样和分销以及产品的广告和促销有关的要求。批准后,对批准产品的大多数更改,如增加新的适应症或其他标签声明,都需要经过FDA的审查和批准。此外,还有针对任何已上市产品的持续的年度计划费用。生物制品制造商和其他参与生产和分销获批生物制品的实体必须在FDA和某些国家机构注册其机构,并接受FDA和某些国家机构的定期突击检查,以确保其符合cGMP要求和其他法律,这些法律对我们和我们的第三方制造商提出了某些程序和文件要求。处方药产品的制造商和药品供应链中的其他参与者也必须遵守产品跟踪和追踪要求,并向FDA通报假冒、挪用、被盗和故意掺假的产品或不适合在美国销售的产品。因此,制造商必须继续在生产和质量控制领域花费时间、金钱和精力,以保持GMP合规。对制造过程或设施的变更受到严格监管,并且根据变更的重要性,可能需要事先获得FDA的批准才能实施。FDA的规定还要求对任何偏离cGMP的行为进行调查和纠正,并对我们和我们可能决定使用的任何第三方制造商提出报告要求。因此,制造商必须继续在生产和质量控制领域花费时间、金钱和精力,以保持符合cGMP和其他方面的监管合规。
如果不遵守监管要求和标准,或者产品进入市场后出现问题,FDA可能会撤回批准。后来发现以前未知的产品问题,包括不良事件
220
未预料到的严重程度或频率,或制造过程,或未能遵守监管要求,可能导致对批准的标签进行修订以增加新的安全信息;强制进行上市后研究或临床研究以评估新的安全风险;或根据REMS计划施加分销限制或其他限制。除其他外,其他潜在后果包括:
| ● | 限制产品的销售或制造,完全退出市场或产品召回; |
| ● | 罚款、警告信或无标题的信件; |
| ● | 临床研究暂停; |
| ● | FDA拒绝批准待决申请或对已批准申请的补充,或暂停或撤销产品许可批准; |
| ● | 产品扣押或扣押,或拒绝准许进口或出口产品; |
| ● | 同意令、企业诚信协议、禁止或排除在联邦医疗保健计划之外; |
| ● | 授权修改宣传材料和标签,并发布纠正信息; |
| ● | 发布安全警告、尊敬的医疗保健提供者信函、新闻稿和其他包含有关产品的警告或其他安全信息的通讯;或 |
| ● | 强制令或施加民事或刑事惩罚。 |
FDA还可能要求上市后测试,即所谓的第4阶段测试,以及监督,以监测批准产品的效果。发现以前未知的产品问题或未能遵守适用的FDA要求可能会产生负面后果,包括负面宣传、司法或行政执法、FDA的警告信、强制性广告或与医生的沟通,以及民事或刑事处罚等。新发现或开发的安全性或有效性数据可能需要更改产品的批准标签,包括添加新的警告和禁忌症,也可能需要实施其他风险管理措施。
FDA严格监管生物制剂的营销、标签、广告和推广。一家公司只能提出那些与安全和功效、纯度和效力有关的声明,这些声明是由FDA批准的,并且符合批准的标签的规定。FDA和其他机构积极执行禁止推广标签外用途的法律法规。联邦政府已对涉嫌不当推广标签外使用的公司处以巨额民事和刑事罚款,并禁止公司从事标签外推广。FDA和其他监管机构还要求公司签订同意法令或永久禁令,根据这些法令,特定的促销行为将被改变或限制。不遵守这些要求,除其他外,可能导致负面宣传、警告信、纠正广告以及可能的民事和刑事处罚。FDA的制裁措施可能包括拒绝批准待审申请、撤回批准、暂停临床、警告或无标题信件、产品召回、产品扣押、全部或部分暂停生产或分销、禁令、罚款、拒绝政府合同、强制性的纠正广告或与医生的沟通、取消资格、恢复原状、返还利润,或民事或刑事处罚。医生可以根据自己独立的专业和医学判断,开出合法可用的产品,用于产品标签中没有描述的用途,以及与FDA测试和批准的用途不同的用途。这种标签外的用途在医学专业中很常见。医生可能认为,对于许多处于不同情况下的患者来说,这种标签外的用途是最好的治疗方法。FDA没有对医生选择治疗方法的行为进行监管。然而,FDA确实会限制制造商就其产品的标签外使用问题进行沟通。
生物仿制药和参考产品的排他性
2010年签署成为法律的《平价医疗法案》包含一个名为《生物制品价格竞争和创新法案》的副标题,该法案为与FDA许可的参考生物制品具有生物相似性或可与之互换的生物制品创建了一个简化的批准途径。FDA发布了几份指导文件,概述了生物仿制药的审查和批准方法。
221
生物相似性要求生物产品和参考产品在安全性、纯度和效力方面没有具有临床意义的差异,可通过分析研究、动物研究和一项或多项临床研究加以证明。可互换性要求产品与参考产品具有生物相似性,并且产品必须证明可以预期在任何特定患者中产生与参考产品相同的临床结果,对于对个人多次给药的产品,在先前给药后,可以交替或转换生物制剂和参考生物制剂,而不会增加安全风险或相对于独家使用参考生物制剂而降低疗效的风险。然而,与生物制品更大、往往更复杂的结构相关的复杂性,以及制造这类产品的过程,对执行FDA仍在制定的简化审批途径构成了重大障碍。
根据BPCIA,在参考产品首次获得FDA许可之日起四年后,才能向FDA提交生物仿制药产品的申请。此外,对于生物仿制药产品的批准,FDA可能要到参照产品首次获得许可之日起12年后才能生效。在这12年的独占期内,如果FDA批准竞争产品的完整BLA包含该申请人自己的临床前数据以及来自充分且控制良好的临床试验的数据,以证明其产品的安全性、纯度和效力,那么另一家公司仍可能销售该参考产品的竞争版本。BPCIA还为被批准为可互换产品的生物仿制药规定了某些独占期。目前,尚不清楚被FDA视为“可互换”的产品是否真的会被受国家药剂法管辖的药店轻易取代。
生物制品还可以在美国获得儿科市场独占权。如果获得儿科独占权,现有的独占期和专利条款将增加六个月。这项为期六个月的专有权,从其他专有权保护或专利期限结束时起算,可根据FDA对此类研究发出的“书面请求”,在自愿完成一项儿科研究的基础上授予。BPCIA是复杂的,继续由FDA解释和执行。此外,政府的提案还试图缩短12年的参考产品独占期。BPCIA的其他方面,其中一些可能影响BPCIA的排他性条款,也是最近诉讼的主题。因此,BPCIA的最终影响、执行和影响具有很大的不确定性。
欧洲联盟条例
无论我们是否为某一产品寻求FDA的批准,我们都必须在开始临床研究或在这些国家销售该产品之前获得外国监管机构的必要批准。美国以外的某些国家也有类似的程序,要求提交临床研究申请,这与人类临床研究开始前的IND非常相似。例如,在欧盟,CTA必须提交给每个国家的国家卫生当局和独立的伦理委员会,就像FDA和IRB一样。一旦CTA按照一个国家的要求获得批准,临床研究的开发工作就可以继续进行。
自2004年以来,欧洲联盟的《2001/20/EC临床试验指令》规范了欧洲联盟临床试验的进行。自2022年1月31日起,(EU)536/2014号条例取代了该指令,并简化和统一了欧盟的临床试验。截至2023年1月31日,所有临床试验申请均提交至(EU)536/2014条例。
这项规定允许临床试验的赞助者只提交一份批准申请,而不论试验将在欧洲联盟的哪个地方进行。所有试验都要经过科学和伦理审查。伦理审查必须由伦理委员会根据有关欧盟成员国的法律进行。欧洲药品管理局建立了一个名为临床试验信息系统的数据库,其中载有在欧洲联盟进行的所有临床试验的信息,无论是否成功。
此外,还有一项具体的欧盟条例(指令2002/98/EC),规定了收集和检测人体血液和血液成分的质量和安全标准,无论其目的是什么,以及准备、储存和分发供输血时的质量和安全标准,以确保高水平的人类健康保护。
本指令不应阻止任何成员国依照《欧洲联盟条约》的规定,在其领土上维持或实行更严格的保护措施。
222
为了完成第2002/98/EC号指令,还通过了另外三项指令:
| ● | 第2004/33/EC号指令:该指令规定了向潜在捐助者和捐助者提供的信息。它还规定了储存、运输和分配的条件以及对血液和血液成分的质量和安全的要求。 |
| ● | 第2005/61/EC号指令:每个会员国必须确保血液和血液成分的可追溯性,以确保其位置和血液成分的制备阶段。报告严重不良反应和严重不良事件的程序必须在每个血液机构内实施,并在每个会员国每年报告。 |
| ● | 经第2016/1214号指令(UE)修订的委员会第2005/62/EC号指令:该指令要求每个成员国确保血液机构的质量体系符合社区标准,即有足够的训练有素的人员承担明确的质量保证任务和责任。房舍必须适合活动、清洁和维护。设备必须经过验证和维护。血液的采集、检测、制备、储存和分配必须保证质量。 |
欧洲联盟委员会公布了一项关于新的欧盟血液、组织和细胞条例的提案草案,并废除了《血液指令》(2002/98/EC)和《组织和细胞指令》(2004/23/EC)。该倡议旨在更新立法,以便更灵活地配合科学和技术发展。
欧洲委员会提出的建议现在将由欧洲理事会和欧洲议会同时讨论。一旦商定并通过最后案文,它将生效,尽管在大多数条款适用之前将有两年的过渡期,而某些特定条款将有三年的过渡期。
管理临床研究、产品许可、定价和报销的要求和程序因国家而异。在所有情况下,临床研究都是根据GCP和适用的监管要求以及源自《赫尔辛基宣言》的伦理原则进行的。
如果我们寻求根据欧盟监管制度获得研究用生物制品的监管批准,我们必须提交上市许可申请。在美国提交BLA的申请与欧盟的申请类似,除了针对特定国家的文件要求之外。欧洲联盟还为市场独占性提供了机会。例如,在欧洲联盟,新的化学品实体在获得销售许可后,一般可获得八年的数据独占权和另外两年的市场独占权。如果获得批准,数据独占性将阻止欧盟监管机构引用创新者的数据来评估一项通用应用。在额外的两年市场独占期内,可以提交仿制药上市许可,并可以参考创新者的数据,但在市场独占期到期之前,任何仿制药产品都不能上市。然而,并不能保证一种产品会被欧盟监管机构视为一种新的化学实体,而且产品可能不符合数据独占性的条件。在欧洲联盟获得孤儿资格的产品可获得十年的市场独占权,在此期间,不得向市场投放针对同一适应症的类似药品。
对于欧洲联盟以外的其他国家,如东欧、拉丁美洲或亚洲国家,有关临床研究、产品许可、定价和报销的要求因国家而异。同样,在所有情况下,临床研究都是根据GCP和适用的监管要求以及源自《赫尔辛基宣言》的伦理原则进行的。
如果我们未能遵守适用的外国监管规定,我们可能会受到罚款、暂停或撤销监管批准、产品召回、产品扣押、经营限制和刑事起诉等处罚。
其他医疗保健法
制药公司受到联邦政府以及它们开展业务的州和外国司法管辖区当局的额外医疗监管和执行,可能会限制财务安排和关系,我们通过这些安排和关系进行研究,以及销售、营销和分销我们获得营销批准的任何产品。这些法律包括但不限于联邦和州的反回扣、欺诈和滥用、虚假索赔、数据隐私和安全以及医生和其他医疗保健提供者的透明度法律和条例。
223
为了在商业上分销产品,我们还必须遵守要求在一个州注册医药产品制造商和批发分销商的州法律,在某些州,包括将产品运入该州的制造商和分销商,即使这些制造商或分销商在该州没有营业场所。一些州还要求制造商和分销商在分销链中建立产品的谱系,包括一些州要求制造商和其他一些州采用能够在产品通过分销链时跟踪和追踪产品的新技术。几个州已颁布立法,要求制药公司建立营销合规计划,向国家提交定期报告,定期公开披露销售、营销、定价、跟踪和报告向医生和其他医疗保健提供者、临床试验和其他活动提供的礼物、补偿和其他报酬,以及/或注册其销售代表,并禁止药店和其他医疗保健实体向制药公司提供某些医生处方数据以用于销售和营销,并禁止某些其他销售和营销做法。我们的所有活动都可能受到联邦和州消费者保护和不公平竞争法的约束。
如果我们的业务被发现违反了上述任何联邦和州医疗法律或适用于我们的任何其他政府法规,我们可能会受到处罚,包括但不限于民事、刑事和/或行政处罚、损害赔偿、罚款、非法所得、监禁、不得参与联邦医疗保险和联邦医疗补助等政府项目、禁令、个人举报者以政府名义提起的私下“qui tam”诉讼,或拒绝允许我们签订政府合同、合同损害、名誉损害、行政负担、利润减少和未来收益,以及削减或重组我们的业务,其中任何一项都可能对我们经营业务的能力和我们的经营业绩产生不利影响。有关与这些合规要求相关的风险的信息,请参阅标题为“风险因素——与政府法规相关的风险”的部分。
保险范围和偿还
任何产品的销售可能在一定程度上取决于第三方付款人,如联邦、州和外国政府的医疗保健计划、商业保险和管理的医疗保健组织,以及第三方付款人对这类产品的补偿水平。关于覆盖范围和偿还数额的决定是在逐个计划的基础上作出的。这些第三方支付者日益减少医疗产品、药品和服务的覆盖范围和报销。为我们的候选产品获得保险和适当的补偿可能特别困难,因为在医生的监督下使用的药物往往价格较高。同样,由于我们的候选产品是由医生管理的,产品本身的单独报销可能会也可能不会。相反,管理医生可能会或可能不会报销提供治疗或程序,我们的产品在其中使用。
此外,美国政府、各州立法机构和外国政府继续实施成本控制计划,包括价格控制、对覆盖面和报销的限制以及对非专利产品替代的要求。采取价格管制和成本控制措施,以及在现有管制和措施的法域采取更具限制性的政策,可能会进一步限制任何产品的销售。第三方对任何产品的补偿减少,或第三方付款人决定不支付产品费用,都可能减少医生对产品的使用和病人对产品的需求,并对销售产生重大不利影响。
医疗改革
不管是国内的还是国外的、政府的还是私人的付款人,都在开发越来越复杂的控制医疗费用的方法,而这些方法并不总是专门适用于干细胞产品和我们正在开发的疗法等新技术。在美国和某些外国司法管辖区,医疗保健系统的一些立法和监管变化可能会影响我们以盈利方式销售产品的能力。
美国于2010年3月颁布了经《医疗保健和教育和解法案》修订的《患者保护和负担得起的医疗费用法案》,统称为《ACA》,这极大地改变了政府和私人保险公司为医疗保健提供资金的方式,并对制药业产生了重大影响。《ACA》载有若干条款,包括关于联邦医疗保健计划的注册、报销调整以及对欺诈和滥用法律的修改。例如,ACA:
| ● | 将名牌药品制造商应支付的医疗补助回扣的最低水平从制造商平均价格的15.1%提高到23.1%; |
224
| ● | 对医疗补助管理的护理组织支付的药品所需收取的回扣; |
| ● | 要求制造商参与一个覆盖缺口折扣计划,根据该计划,他们现在必须同意在其覆盖缺口期间向符合条件的受益人提供适用品牌药品谈判价格的70%销售点折扣,作为制造商的门诊药品在联邦医疗保险D部分下覆盖的条件;以及 |
| ● | 对向特定联邦政府项目销售“品牌处方药”的制药商或进口商征收不可扣除的年费。 |
2021年6月17日,美国最高法院驳回了几个州对《ACA》提出的最新司法挑战,但没有对《ACA》的合宪性做出具体裁决。在最高法院做出裁决之前,拜登总统发布了一项行政命令,启动从2021年2月15日至2021年8月15日的特殊注册时间,以便通过ACA市场获得医疗保险。该行政命令还指示某些政府机构审查和重新考虑限制获得医疗服务的现有政策和规则,包括重新审查医疗补助示范项目和包括工作要求的豁免计划,以及对通过医疗补助或ACA获得医疗保险造成不必要障碍的政策。目前尚不清楚拜登政府的其他医疗改革措施,或其他挑战废除或取代ACA的努力,将如何影响我们的业务。
自《平价医疗法案》颁布以来,美国还提出并通过了其他立法改革。例如,2021年3月11日,拜登总统签署了《2021年美国救援计划法案》,使之成为法律,从2024年1月1日起,该法案取消了针对单一来源和创新多来源药物的法定医疗补助药品回扣上限,目前该上限为药品平均制造商价格的100%。此外,2011年8月,除其他外,2011年《预算控制法》制定了国会削减开支的措施。赤字削减联合特别委员会的任务是建议在2013年至2021年期间削减至少1.2万亿美元的目标赤字,但该委员会未能达到要求的目标,从而导致该立法自动削减了几个政府项目,包括每个财政年度将联邦医疗保险支付总额削减2%。这些削减措施于2013年4月生效,由于随后对《规约》进行了立法修订,除非国会采取进一步行动,否则这些削减措施将一直有效到2030年。根据《冠状病毒援助、救济和经济安全法》(又称《CARES法》)以及随后的立法,由于新冠疫情,这些削减已从2020年5月1日至2021年12月31日暂停。
此外,2018年5月30日,《审判权利法》签署成为法律。除其他事项外,该法律为某些患者提供了一个联邦框架,使他们能够接触到某些已完成1期临床试验并正在接受FDA批准的调查的研究新药产品。在某些情况下,符合条件的患者无需参加临床试验,也无需根据FDA扩大准入计划获得FDA许可即可寻求治疗。制药商没有义务根据《审判权利法》向符合条件的患者提供其药品。
此外,政府最近加强了对制造商为其销售产品定价的方式的审查,这导致国会进行了几次调查,提出并颁布了立法和上届政府发布的行政命令,其目的包括提高产品定价的透明度,审查定价与制造商患者项目之间的关系,以及改革政府项目对药品的报销方法。由上届政府发起的这些措施和其他措施取得成功的可能性尚不确定,特别是考虑到新一届拜登政府。政府也有可能针对新冠疫情采取更多行动。美国各州也越来越积极地实施旨在控制医药产品定价的法规,包括价格或患者报销限制、折扣、对某些产品准入的限制以及营销成本披露和透明度措施,在某些情况下,还鼓励从其他国家进口和批量采购。
资料私隐及保安法例
在我们成立的司法管辖区,或在我们销售或营销我们的产品或进行临床试验的司法管辖区,我们也受到或将受到隐私法的约束。例如,在欧洲,我们在收集、控制、处理和以其他方式使用个人数据(即与可识别的在世个人有关的数据)方面受到GDPR的约束。我们处理与我们在欧洲经济区的临床试验参与者有关的个人数据,包括这些参与者的健康和医疗信息。GDPR还规定,个别欧洲经济区国家可以引入自己的进一步条件,包括可能限制我们收集、使用和分享个人数据的能力的限制。
225
GDPR规定了繁重的问责义务,要求数据控制者和处理者保持其数据处理的记录,并实施政策,作为其规定的隐私治理框架的一部分。它还要求数据控制者保持透明,并向数据主体披露如何使用他们的个人信息(以简明、易懂和易于获取的形式);对个人数据的保留施加限制;定义假名(即键码)数据;引入强制性数据泄露通知要求;并为数据控制者设定更高标准,以证明他们已就某些数据处理活动获得有效同意。某些违反GDPR的行为将被处以高额罚款:最高可达2000万欧元或全球年度总营业额的4%,两者以较高者为准。违反GDPR或其他适用的隐私和数据保护法律法规也可能导致监管调查、声誉受损、命令停止/改变我们对数据的使用、执行通知或潜在的民事索赔,包括集体诉讼类型的诉讼。此外,从2021年1月1日起,我们必须遵守GDPR和单独的英国GDPR,后者与修订后的《2018年英国数据保护法》一起,在英国国家法律中保留了GDPR。GDPR和英国GDPR各有权处以2000万欧元/1700万英镑或占全球营业额4%的较大者的罚款。此外,联合王国与欧洲联盟之间在数据保护法的某些方面的关系仍不明确,包括如何处理欧洲联盟成员国与联合王国之间的数据转移,以及联合王国数据保护法律和条例在中长期内将如何发展。目前,欧盟和联合王国的《贸易与合作协定》商定了4至6个月的宽限期,最迟将于2021年6月30日结束,同时各方将讨论是否适当的决定。欧盟委员会于2021年2月19日公布了一份充分性决定草案。如果获得通过,该决定将使欧洲联盟成员国能够向联合王国转让为期四年的数据,但可随后延期。这些变化可能导致额外的合规成本,并可能增加我们的整体风险。
此外,GDPR还对跨境数据传输设置了限制。GDPR规定的跨境数据转移的某些方面由于欧盟的法律程序而不确定,包括欧盟法院最近的一项裁决,该裁决使欧盟-美国隐私盾无效,并在某种程度上使使用标准合同条款的效力和合法性受到质疑。这可能会增加跨境转移个人数据的复杂性。GDPR将增加我们在处理受GDPR约束的个人数据方面的责任和义务,我们可能需要建立额外的机制来确保遵守GDPR,包括个别国家实施的机制。我们还须遵守欧洲联盟关于个人数据从欧洲经济区跨境转移的规则。欧盟最近的法律发展导致了将个人数据从欧洲经济区转移到其他国家(包括美国)的复杂性和不确定性,这些国家的数据保护标准未被欧盟委员会视为“足够”。2020年7月16日,欧盟法院宣布欧盟-美国“隐私盾”框架无效,根据该框架,个人数据可以从欧洲经济区转移到根据“隐私盾”计划进行自我认证的美国实体。虽然欧洲法院坚持标准合同条款(欧洲联盟委员会批准的一种标准合同形式,作为适当的个人数据传输机制)在某些条件下是适当的,但未来的监管指导可能导致标准合同条款的使用发生变化。随着监管机构发布有关个人数据输出机制的进一步指导,包括不能使用标准合同条款的情况,和/或开始采取执法行动,我们可能会遭受额外费用、投诉和/或监管调查或罚款,和/或如果我们无法在我们将开展业务的国家和地区之间传输个人数据,这可能会影响我们提供服务的方式、地理位置或我们相关系统和业务的隔离,并可能对我们的财务业绩产生不利影响。
此外,英国退出欧盟(通常被称为英国退欧)给英国的数据保护监管带来了不确定性。具体而言,英国于2020年1月1日退出欧盟,但过渡期截至2020年12月31日。根据退欧后欧盟与英国之间的《贸易与合作协定》,英国和欧盟已达成协议,自2021年1月1日起,将个人数据从欧洲经济区成员国转移至英国的做法,在长达4个月的时间内,不会被视为向非欧洲经济区国家的“限制性转移”,并可能进一步延长两个月,即延长适足评估期。尽管目前延长适足性评估期的最长期限为六个月,但如果欧盟委员会就英国通过适足性决定,或者英国修订英国GDPR和/或在未经欧盟同意的情况下对英国GDPR/《2018年数据保护法》下的数据传输做出某些更改,则该期限可能提前结束(除非这些修订或决定仅仅是为了使相关的英国法律与欧盟的数据保护制度保持一致)。如果欧盟委员会在延长的适足评估期结束前没有就英国做出“适足性决定”,那么从那时起,英国将成为GDPR规定的“不适足的第三国”,而将个人数据从欧洲经济区转移到英国将需要一个“转移机制”,如标准合同条款。
在美国,许多联邦和州的法律法规,包括数据泄露通知法、健康信息隐私和安全法,包括HIPAA,以及联邦和州消费者保护法律法规(例如,联邦贸易委员会法案第5节),这些法律法规规范了健康相关信息和其他个人信息的收集、使用、披露和保护,可适用于我们的业务或我们的合作伙伴的业务。此外,某些州的法律管辖隐私和安全
226
个人信息,包括在某些情况下与健康相关的信息,其中一些信息比HIPAA更严格,而且许多信息彼此之间存在重大差异,可能不会产生相同的效果,从而使合规工作复杂化。例如,加利福尼亚州颁布了《CCPA》,为加利福尼亚州的消费者规定了个人隐私权(如法律所界定),并对处理消费者或家庭的某些个人数据的实体规定了更多的隐私和安全义务。CCPA要求相关公司向消费者提供有关此类公司数据收集、使用和共享做法的新信息,为此类消费者提供选择不出售或转让某些个人信息的新途径,并为消费者提供其他诉讼理由。CCPA规定了对违规行为的民事处罚,以及对导致个人信息丢失的某些数据泄露行为的私人诉讼权。这种私人诉讼权可能会增加数据泄露诉讼的可能性和相关风险。CCPA于2020年1月1日生效,(a)允许加州总检察长对违规行为实施民事处罚,(b)授权私人诉讼为某些数据泄露行为追回法定损害赔偿金。此外,美国所有50个州的法律都要求企业向因数据泄露而泄露个人信息的消费者提供通知。各州的法律正在迅速变化,美国国会正在讨论一项新的全面的联邦数据隐私法,如果该法律获得通过,我们将成为该法律的主体。CCPA可能会影响我们的业务活动,并说明我们的业务容易受到与个人数据和受保护的健康信息相关的不断变化的监管环境的影响。此外,加州最近通过了修订CCPA的《加州隐私权法案》。CPRA大幅修改了CCPA,并对涵盖的企业规定了额外的数据保护义务,包括额外的消费者权利程序、对数据使用的限制、对高风险数据的新审计要求,以及对敏感数据的某些使用的选择退出。它还将扩大受CCPA私人诉讼权约束的数据泄露类型,增加对涉及16岁以下加州居民的CPRA违规行为的处罚,并创建一个新的加州数据保护机构,授权发布实质性法规,并可能导致隐私和信息安全执法力度的加强。大部分规定将于2023年1月1日生效,可能需要额外的合规投资和潜在的业务流程变更。确保遵守CPRA可能需要我们承担额外的成本和开支。
为了在商业上分销产品,我们必须遵守要求在一个州注册医药产品制造商和批发分销商的州法律,在某些州,包括将产品运入该州的制造商和分销商,即使这些制造商或分销商在该州没有营业场所。一些州还要求制造商和分销商在分销链中建立产品的谱系,包括一些州要求制造商和其他一些州采用能够在产品通过分销链时跟踪和追踪产品的新技术。几个州已颁布立法,要求制药公司建立营销合规计划,向国家提交定期报告,定期公开披露销售、营销、定价、跟踪和报告向医生和其他医疗保健提供者、临床试验和其他活动提供的礼物、补偿和其他报酬,以及/或注册其销售代表,并禁止药房和其他医疗保健实体向制药公司提供某些医生处方数据以用于销售和营销,并禁止某些其他销售和营销做法。我们的所有活动都可能受到联邦和州消费者保护和不公平竞争法的约束。
如果我们的业务被发现违反了上述任何联邦和州的医疗保健和隐私法律或任何其他适用于我们的政府法规,我们可能会受到处罚,包括但不限于民事、刑事和/或行政处罚、损害赔偿、罚款、非法所得、监禁、不得参与联邦医疗保险和联邦医疗补助等政府项目、禁令、个人告密者以政府名义提起的私下“qui tam”诉讼,或拒绝允许我们签订政府合同、合同损害、名誉损害、行政负担、利润减少和未来收益,以及削减或重组我们的业务,其中任何一项都可能对我们经营业务的能力和我们的经营业绩产生不利影响。有关与这些合规要求相关的风险的信息,请参阅标题为“风险因素——与政府监管相关的风险”的部分。
有效化妆品的规管
我们开发的AHSDM和任何活性化妆品产品将受我们开展活性化妆品业务的每个司法管辖区的法律法规的约束。目前,我们除了在允许我们以最小的监管相关成本和要求销售AHSDM和开发我们的产品的司法管辖区寻求机会。我们计划继续监测和分析活性化妆品领域的监管变化,因为我们评估与商业伙伴和潜在分销商的机会,我们可能开发的产品。
在美国,FDA有权在美国监管化妆品及其成分。这一授权是由1938年《联邦食品、药品和化妆品法》(FFDCA)授予的,该法包括关于化妆品掺假和品牌错误的规定。化妆品产品也受到《公平包装和标签法》(FPLA)和相关立法的监管。这
227
FDA对化妆品的权威不如对其他受FDA监管的产品的权威全面。例如,在注册、测试、上市前通知、审批、批准、良好生产规范、强制性风险标签、不良事件报告和召回方面,该机构的权限相对有限。此外,FDA没有对化妆品制造商提出注册要求。相反,制造商在向FDA注册时,可能会决定遵守FDA的自愿规定。除颜色添加剂外,FDA不要求对化妆品中使用的化学品进行上市前通知、安全测试、审查或批准。尽管FDA已经发布了针对化妆品制造商的良好生产规范(GMP)指南,但并没有要求他们使用这些指南,也没有要求制造商向FDA提交成分信息,或向FDA报告不良反应。相反,根据FDA的一项自愿计划,化妆品制造商和包装商可以报告其产品配方中使用的成分。FDA无权要求制造商从市场上召回化妆品,尽管该机构发布了关于自愿召回的一般性规定。该机构发布化妆品法规的能力受到该机构法定机构或缺乏法定机构的限制。
在欧盟,欧洲议会和欧洲理事会2009年11月30日关于化妆品的第1223/2009号条例(《欧盟化妆品条例》)具有很强的限制性。《欧盟化妆品条例》将化妆品定义为旨在与人体外部部位(包括皮肤)接触的任何物质或混合物,目的是清洁、喷香、改变其外观、保护、保持其良好状态或纠正体味。化妆品中使用的成分必须符合欧盟化妆品条例附件二(违禁物质)、三(限制物质)、四(授权作为着色剂的物质)、五(授权作为防腐剂的物质)和六(授权作为紫外线过滤器的物质)。根据附件二,“人类来源的细胞、组织或产品”被禁止用于化妆品。因此,根据欧盟化妆品条例,使用成人干细胞、组织或产品的化妆品产品的商业化是被禁止的,这影响了我们在欧盟国家使用AHSDM营销和销售活性化妆品产品的能力。
市场营销
在美国,联邦贸易委员会(Federal Trade Commission,简称FTC)的消费者保护局(Bureau of Consumer Protection of the Federal Trade Commission,简称FTC)负责保护美国消费者免受虚假、误导或欺骗性广告的侵害。美国联邦贸易委员会的重点是宣传不准确的健康声明的广告,包括据称能带来健康益处的膳食补充剂和食品,以及各种疾病和病症的治疗方法。美国联邦贸易委员会与美国食品和药品管理局密切合作,以实现这一使命。根据《食品、药品和化妆品法》,为未经FDA批准的干细胞疗法做广告是严重违法行为。FDA可以选择通过民事或刑事执法部门,对一家鼓吹使用未经批准的干细胞的实体提起诉讼。根据具体情况,民事诉讼可以从警告信开始。如果不听从警告,行动可能升级为诉讼、扣押和其他直接规范涉案人员行为的命令。
在FDA判定对人类健康构成更大威胁的情况下,该机构也可能会采取刑事行动,而且它已经对未经证实的干细胞用途采取了行动。一般来说,但并非总是如此,FTC对广告负有主要责任,而FTC和FDA都对互联网营销拥有权力。面对干细胞疗法等新出现的科学问题,FTC经常向FDA寻求有关科学问题的指导。然而,FTC执行的是自己的法规,而不是《食品、药品和化妆品法》。关于健康索赔,联邦贸易委员会只有在能够证明索赔是虚假的或具有欺骗性的情况下才能采取行动;因此,问题在于是否有足够的科学证据支持索赔。
我们计划制定一项营销政策,以确保我们遵守我们将在哪些司法管辖区开展业务的营销和广告相关法规。
进出口管制
如果我们开发和商业化我们的产品,我们将受到涉及生物材料交付的进出口法规的约束。在某些司法管辖区,我们可能需要获得许可证、许可证或其他授权才能将我们的产品出口到这些司法管辖区。具体来说,在获得FDA批准之前,我们可能需要获得许可证或证书才能出口我们的通用红细胞。此外,FDA或其他监管机构可能要求广泛的记录保存和其他管理要求。我们还可能受到检查、关税、关税或与进出口条例有关的其他费用。我们计划制定一项政策,确保在我们将开展业务的司法管辖区遵守进出口法规。
228
研究与开发
在过去的二十年里,斯里瓦斯塔瓦博士和帕特尔先生投入了大量的时间和精力来创建我们现有的授权知识产权。我们期望继续努力进行研究和开发,以找到改进我们的治疗方法和产品的途径,并在适用的情况下改进我们的技术。我们相信,我们的团队拥有科学背景,可以在他们之前的成就基础上,通过战略研发进一步扩大我们产品的覆盖范围。
制造业
我们目前不拥有或经营任何制造设施。我们目前正在与制造商进行谈判,以开始设计一个原型生物反应器,以测试我们的通用红细胞的大规模生产。虽然我们未来可能会收购或建造我们自己的制造设施和实验室,但就近期而言,我们将依靠合同制造组织(“CMO”)根据我们的测试配方生产我们的产品,并依靠GIOSTAR供应纳入我们的活性化妆品的AHSDM。对于我们的抗衰老诊所,我们计划在美国以外的主要市场为我们的GIO拥有的抗衰老诊所寻求许可安排。我们还计划与医生和其他医疗提供者(作为被许可人)建立伙伴关系,这些被许可人将利用他们自己的空间来提供我们的产品和服务。今后,这种办公空间可能包括我们能够制造或部分制造干细胞产品的实验室。
市场营销
我们将依靠各种在线营销公司,将我们的诊所和活性化妆品推到公众意识的最前沿,以追求潜在的定量销售。未来,我们可能会选择扩大我们的内部团队,包括营销专业人员。干细胞治疗药物的销售须遵守因管辖权不同而不同的规定。有关与我们的营销工作有关的监管考虑的更多信息,请参阅上文的“政府监管-营销”。
许可证和协作协议
我们目前与GIOSTAR签署了一份日期为2021年12月8日、并于2023年2月14日修订的知识产权许可协议(“现有GIOSTAR许可协议”),根据该协议,GIOSTAR在某些司法管辖区授予我们一项独家许可,用于商业使用和利用与前面讨论的业务线相关的某些知识产权。在完成业务合并之前,GIOSTAR将与我们签订一份经修订和重述的许可协议(“GIOSTAR许可协议”),该协议将授予我们全球独家许可(哥斯达黎加、印度和墨西哥的抗衰老诊所除外,GIOSTAR目前在这些国家经营自己的抗衰老诊所)GIOSTAR的商业秘密、专有技术和其他机密和专有信息,包括与制造或使用干细胞或干细胞衍生物(包括基于干细胞的红细胞)有关的发明、协议、工艺、配方、数据和研究成果,以开发、改进、制造、已经制造,在以干细胞为基础的化妆品和服务、以干细胞为基础的全民献血红细胞、献血和全民献血计划、以干细胞为基础的COVID和长期COVID治疗、抗衰老诊所和以干细胞为基础的抗衰老疗法、产品和服务领域,进口、使用、体现、使用或实践或使用任何许可知识产权的产品和服务(“许可产品”),销售、分销或以其他方式进行商业开发。
我们计划将根据GIOSTAR许可协议授予我们的许可权的再许可,授予我们为每个业务线、每个此类子公司的特定业务线成立的全资子公司。
知识产权
我们的成功在一定程度上取决于我们是否有能力为我们的产品以及对我们的业务运作至关重要的其他发现、发明、商业秘密和专门知识获得和维持专利保护。它还部分取决于我们在不侵犯他人所有权的情况下开展业务的能力,部分取决于我们防止他人侵犯我们的所有权的能力。
额外知识产权
我们还依靠商业秘密,包括专门知识、机密信息、非专利技术和其他专有信息,来加强或提高我们的竞争地位。作为商业秘密,我们保留与我们目前正在开发的产品和流程有关的信息,以及与我们的业务战略和业务方法有关的信息。然而,商业秘密和保密专门知识很难得到保护。避免因疏忽和不当披露商业秘密,并
229
保护我们的商业秘密,避免前雇员为了自身利益或第三方利益而使用这些商业秘密的风险,我们的政策是要求有权获取我们商业秘密的雇员、顾问和独立承包商执行保密协议,并将他们在受雇于我们或为我们提供服务时开发的知识产权的所有权利转让给我们。
我们还将通过与第三方签订的协议中的保密条款,明确保护我们现有的许可知识产权和发展知识产权。然而,无法保证这些协议将自动执行,或以其他方式为我们的商业秘密或其他知识产权或专有信息提供有意义的保护,或在未经授权使用或披露此类商业秘密或其他知识产权或专有信息的情况下提供适当的补救。我们还力求维护我们的商业秘密和其他机密信息的完整性和保密性,方法是维护我们房地的实体安全以及我们信息技术系统的实体和电子安全。虽然我们对我们为保护和维护我们的商业秘密而采取的措施有信心,但这种措施是可以违反的,而且我们可能对任何这种违反行为都没有适当的补救办法。此外,我们的商业秘密可能会被竞争对手知晓或独立发现。
我们打算寻求更多的知识产权保护,只要我们认为这将推进我们的业务目标,其中可能包括美国国内外的目标。尽管我们努力保护我们的知识产权,但这些权利在未来可能不会得到尊重,或者在我们拥有知识产权的任何司法管辖区的法律程序中可能被规避或挑战(并可能被取消)。此外,不同国家的法律可能无法提供与美国法律同等程度的保护或保证。有关这些风险和其他与知识产权相关的风险的更多信息,请参见标题为“风险因素-与GIO知识产权相关的风险”的部分。
雇员和人力资本
截至2023年5月11日,GIO有两名员工,我们的首席执行官帕特尔先生和首席科学官斯里瓦斯塔瓦博士。我们认为我们与员工的关系很好。随着我们业务的发展和扩展,我们将需要扩大我们的员工队伍,包括信息技术和会计专业人员。
我们的人力资本资源目标包括酌情确定、招聘、留住、激励和整合我们现有的和额外的雇员。
设施
我们的公司总部位于加利福尼亚州圣迭戈,根据2023年3月开始的办公室共享协议,我们在那里与GIOSTAR共享办公空间。我们认为,我们现有的设施足以满足我们的近期需要,但随着我们的发展,我们预计将需要更多的空间。我们认为,今后将根据需要,以商业上合理的条件提供适当的额外或替代空间。
法律程序
虽然我们在正常过程中可能会受到诉讼,但我们目前并不是任何重大法律诉讼的一方。
230
MANAGEMENT’s DISCUSSION ANALYSIS OF FINANCIAL CONDITION AND RESULTS OF OPERATIONS OF GIO
您应阅读以下关于GIO财务状况和业务结果的讨论和分析,并结合题为“选定的综合财务数据”的一节和GIO的综合财务报表以及本代理报表/招股说明书其他部分所载的相关说明。本讨论包含涉及风险和不确定性的前瞻性陈述。由于各种因素的影响,GIO的实际结果和选定事件发生的时间可能与这些前瞻性陈述中的预期存在重大差异,这些因素包括在“风险因素”和本代理声明/招股说明书的其他部分中列出的因素。
概述
GIO是一家处于发展阶段的生命科学公司,计划在全球开发和分销精选的干细胞产品和服务。由GIO官员控制的实体GIOSTAR将授予我们使用GIOSTAR商业机密、专有技术和其他机密和专有信息的许可,包括发明、协议、工艺、配方、数据和专有研究成果,以进一步开发和商业化四个干细胞相关领域的产品和服务:全民捐献红细胞、抗衰老、活性化妆品和COVID治疗。
GIO成立于2021年,目前尚未实现收入,迄今尚未运营。GIO目前的战略重点是开发三个主要领域的产品和服务:抗衰老诊所、通用红细胞和活性化妆品。尽管GIO并不认为它会成为其未来主要关注的领域之一,但GIOSTAR还向GIO授予了使用其干细胞技术进行COVID相关疗法的许可。
GIO的长期目标是成为一家领先的基于干细胞的生命科学公司,专注于开发和商业化基于干细胞的产品和服务。为实现这一目标,GIO目前计划在三个主要部门或“业务线”发展能力,如下所述:
| ● | 抗衰老诊所。GIO计划在美国以外的主要市场开发GIO旗下的抗衰老诊所,提供基于成人间充质干细胞(MSC)的专有疗法。GIO计划让GIO拥有的诊所由GIO雇用的医生、护士、科学家和支持人员运营。GIO还希望利用其管理团队与医疗供应商的关系和网络,寻求与美国以外现有医疗机构达成许可协议。 |
| ● | 通用红细胞。GIO计划开发利用生物反应器生产通用红细胞的能力。通用红细胞的生产力求解决全世界每年估计短缺1亿单位(品脱)血液的问题,这些血液用于各种医疗程序、应急方案、政府和军事用途以及研究和开发目的。假设GIO开发了生产其通用红细胞的能力,GIO计划寻求FDA的批准,并期望将其通用红细胞推向市场。 |
| ● | 活性化妆品。GIO预计将达成协议,将AHSDM出售给现有的化妆品企业,纳入这些公司的产品。随着时间的推移,GIO可能还会开发自己的Active Cosmetics系列或包含GIOSTAR提供的AHSDM的产品。GIO认为AHSDM可以纳入的“活性化妆品”产品包括但不限于抗皱产品、面部精华液、日间护肤霜、眼底抗皱精华液、高端面霜和头发活力配方。 |
GIO的管理层计划为执行其战略而承担大量成本。具体而言,GIO预计将在以下方面产生费用:(i)开设抗衰老诊所并雇用专业人员经营此类诊所;(ii)建造原型生物反应器以生产通用红细胞;以及(iii)开发活性化妆品。
外币翻译
GIO的历史财务报表已换算成美元,并在本节中以美元列报,使用的是(1)经营业绩、2022年1月1日至2022年12月31日期间的平均汇率1.2369美元/1.00英镑、2021年1月1日至2021年12月31日期间的平均汇率1.3757美元/1.00英镑,以及现金流量,截至2022年12月31日,资产负债表日的现行汇率为1.2098美元/1.00英镑,截至2021年12月31日为1.3532美元/1.00英镑。
231
业务成果的组成部分
收入
迄今为止,GIO尚未产生任何收入。
费用
GIO的支出主要包括一般和管理费用。一般和行政费用主要包括专业和营销费用。
截至2022年12月31日和2021年12月31日止年度的经营业绩
|
美元 |
|
美元 |
|
英镑 |
|
英镑 |
|
|
12/31/2022 |
12/31/2021 |
12/31/2022 |
12/31/2021 |
||||||
服务收入 |
|
|
|
|
|||||
收入 |
0 |
0 |
0 |
0 |
|||||
收益成本 |
0 |
0 |
0 |
0 |
|||||
毛利 |
0 |
0 |
0 |
0 |
|||||
公司费用 |
322 |
234 |
|
|
|||||
专业费用 |
121,071 |
97,883 |
|
|
|||||
广告与营销 |
95,265 |
77,019 |
|
|
|||||
差旅费 |
12,905 |
10,433 |
|
|
|||||
一般和行政费用 |
12,855 |
681 |
10,393 |
495 |
|||||
营业费用 |
242,096 |
1,002 |
195,728 |
729 |
|||||
所得税前亏损 |
(242,096) |
(1,002) |
(195,728) |
(729) |
|||||
所得税费用 |
— |
— |
|
|
|||||
净损失 |
(242,096) |
(1,002) |
(195,728) |
(729) |
一般和行政费用
由于GIO目前没有生产、销售或销售费用,因此在截至12月31日的两个年度以及2022年和2021年,一般和管理费用仅包括一般和管理费用。一般和行政费用从截至2021年12月31日止年度的1002美元增加到截至2022年12月31日止年度的242096美元,增加了241094美元,主要是由于与法律、审计和营销相关的专业和营销费用增加。
净损失
净亏损从截至2021年12月31日止年度的1002美元增加到截至2022年12月31日止年度的242096美元,增加241094美元,主要是由于与法律、审计和营销相关的专业和营销费用增加。
流动性和资本资源
截至2022年12月31日和2021年12月31日,GIO的现金和现金等价物分别为17791美元和101519美元。自成立以来,GIO一直亏损,经营活动产生的现金流为负。GIO的运营资金主要来自GIO的管理和销售普通股的自筹资金。我们预计在可预见的将来将继续蒙受损失,可能需要筹集更多的资金来执行我们的发展倡议。
GIO的长期流动性需求主要与以下方面的预期费用有关:(i)制造用于生产通用红细胞的原型生物反应器;(ii)在美国境外为GIO拥有的抗衰老诊所物色和收购或租赁适当的空间;与在美国境外授权GIO的抗衰老诊所有关的积极营销;以及(iii)开发、制造和营销GIO的Active Cosmetics业务线。
232
未来任何融资的来源、时机和可得性将主要取决于市场条件。可能根本无法在需要时获得资金,也可能无法按照GIO可接受的条件获得资金。缺乏必要的资金可能要求GIO除其他外,推迟、缩减或缩减部分或全部计划发展,并采取额外措施降低成本,以节省足以维持业务的现金。这些措施可能会严重延误我们的业务计划。
随着业务合并的成功完成,GIO相信它将有足够的营运资金在交易完成后的九至十二个月内开始(i)制造其原型生物反应器,(ii)为GIO在美国境外拥有的抗衰老诊所物色和收购或租赁适当的空间,(iii)与GIO在美国境外的抗衰老诊所授权相关的营销工作,以及(iv)在GIO的Active Cosmetics业务线中营销AHSDM或产品。GIO认为,如果ACIC股东进一步赎回,这些计划不会受到重大不利影响。如果需要额外资金来支持GIO的营运资金需求和其他用途,GIO可能会寻求通过股权和债务融资或其他来源筹集额外资金。如果GIO通过从第三方获得贷款来筹集额外资金,这些融资安排的条款可能包括对GIO业务的负面契约或其他限制,这可能会损害GIO的经营灵活性,并要求GIO产生利息费用。如果GIO通过发行股票筹集更多资金,GIO股东的持股比例可能会被稀释。GIO不能保证有额外的融资,也不能保证如果有的话,GIO能够以对GIO有利的条款获得额外的融资。
截至2022年12月31日和2021年12月31日止年度的现金流量
截至2022年12月31日,我们的现金和现金等价物约为17791美元,而截至2021年12月31日,我们的现金和现金等价物为101519美元。下表汇总了截至2022年12月31日和2021年12月31日止年度的现金流量活动:
|
美元 |
|
美元 |
|
英镑 |
|
英镑 |
|
|
年终 |
年终 |
年终 |
年终 |
||||||
12/31/2022 |
12/31/2021 |
12/31/2022 |
12/31/2021 |
||||||
净损失 |
(242,096) |
(1,002) |
(195,728) |
(729) |
|||||
货币换算调整数 |
11 |
1,086 |
(9) |
790 |
|||||
为将净亏损与业务活动所用现金净额对账而作出的调整: |
|
|
|
|
|||||
预付存款 |
143,404 |
(173,039) |
115,938 |
(125,783) |
|||||
应付账款 |
0 |
0 |
0 |
0 |
|||||
经营活动所用现金净额 |
(98,702) |
(172,955) |
(79,798) |
(125,722) |
|||||
投资活动产生的现金流量 |
0 |
0 |
0 |
0 |
|||||
筹资活动产生的现金流量 |
|
|
|
|
|||||
上一年度货币调整 |
(955) |
0 |
(790) |
0 |
|||||
股东收益 |
13,768 |
283,679 |
11,380 |
209,636 |
|||||
筹资活动提供的现金净额 |
12,812 |
283,679 |
10,590 |
209,636 |
|||||
期初现金及现金等价物 |
101,519 |
0 |
83,914 |
0 |
|||||
期末现金及现金等价物 |
17,791 |
101,519 |
14,706 |
83,914 |
|||||
补充披露: |
|
|
|
|
|||||
已付利息 |
0.00 |
0.00 |
0.00 |
0.00 |
|||||
已缴税款 |
0.00 |
0.00 |
0.00 |
0.00 |
业务活动
截至2022年12月31日止年度,用于经营活动的现金净额为(98702美元),而截至2021年12月31日止年度为(172955美元)。减少的主要原因是2021年预付的法律费用在2022年没有重复。
投资活动。
截至2022年12月31日和2021年12月31日止年度,投资活动提供的现金为0美元。
筹资活动。
截至2022年12月31日止年度,筹资活动提供的现金为12812美元。这包括向GIO现有股东非公开发行股票的收益。
截至2021年12月31日止年度,筹资活动提供的现金为283679美元。这包括向GIO现有股东非公开发行股票的收益。
233
资产负债表外安排
在报告所述期间,我们没有,目前也没有任何根据美国证交会规则和条例定义的表外安排。
关键会计政策
这份“管理层对财务状况和经营成果的讨论和分析”是基于我们的财务报表,这些报表是根据美国公认会计原则(“GAAP”)编制的。编制财务报表要求管理层作出影响所报告的资产、负债和费用数额的估计和假设。这些估计和假设受到管理层采用会计政策的影响。我们认为,了解我们财务报表以下方面所涉及的估计和假设的基础和性质,对于理解我们的财务报表至关重要。
在编制财务报表时使用估计数
按照公认会计原则编制财务报表,要求管理层作出估计和假设,这些估计和假设会影响资产和负债的呈报数额,以及在财务报表日披露或有资产和负债以及在每个报告期内呈报的净收入和支出数额。实际结果可能与这些估计数不同。
现金
GIO认为,所有购买的原始到期日为三个月或更短的短期高流动性投资都是现金等价物。
收入确认
在截至2022年12月31日的期间,GIO的收入确认政策符合ASC 606,即“与客户签订的合同的收入”,该规定要求按照以下五个步骤确认销售:(一)确定与客户签订的合同;(二)确定合同中的履约义务;(三)确定交易价格;(四)将交易价格分配给合同中的履约义务;(五)在实体履行履约义务时确认收入。
由于没有收入,GIO没有属于ASC 606范围的重大合同资产或负债。
每股普通股净亏损----基本亏损和稀释亏损
关于每股收益的权威指导要求对所有资本结构复杂的实体的基本和稀释每股收益或亏损(“EPS”)进行双重列报,并要求对基本每股收益计算的分子和分母与稀释每股收益计算的分子和分母进行调节。基本每股收益不包括稀释;稀释每股收益反映了如果发行普通股的证券或其他合同被行使或转换为普通股,或导致发行普通股,然后分享实体的收益,则可能发生的稀释。
每股基本亏损的计算方法是将适用于普通股股东的净亏损除以该期间已发行普通股的加权平均数。稀释每股亏损反映了如果稀释性证券和其他发行普通股的合同被行使或转换为普通股,或导致发行普通股,然后分享GIO的收益,则可能发生的稀释,除非其效果是减少亏损或增加每股收益。
股票补偿
根据ASC第718号《补偿——股票补偿》(简称ASC 718),GIO根据授予日的公允价值计量基于股票的补偿安排的补偿成本,并在财务报表中确认员工需要提供服务的期间的成本。
截至2022年12月31日,没有发行或未偿还的股票奖励。
234
金融工具的公允价值
我们使用会计准则编纂(ASC)820,公允价值计量和披露中建立的公允价值层次对我们的金融资产和负债进行经常性估值。
ASC 820描述了可用于计量公允价值的三个层次的投入,如下:
| ● | 第1级投入,包括相同资产或负债在活跃市场中的报价。 |
| ● | 第二级投入,包括第一级投入以外的可观察投入,如类似资产或负债的报价;不活跃市场中相同或类似资产或负债的报价;或在资产或负债的整个期限内可观察或可由可观察市场数据证实的其他投入;以及 |
| ● | 第3级投入,包括很少或根本没有市场活动支持的、对基础资产或负债的公允价值具有重要意义的不可观测投入。第3级资产和负债包括其公允价值计量采用定价模型、贴现现金流量方法或类似估值技术以及管理层的重大判断或估计确定的资产和负债。 |
所得税
根据ASC主题740“所得税”,GIO使用资产和负债法核算所得税。根据这一方法,所得税费用的确认数额为:(一)当年应交或可退还的税款和(二)因实体财务报表或纳税申报表中已确认的事项而产生的暂时性差异所产生的递延税款后果。递延所得税资产和负债采用预期在这些暂时性差异有望收回或结算的年份适用于应纳税所得额的已颁布税率计量。税率变动对递延所得税资产和负债的影响在包括颁布日期在内的期间的经营业绩中确认。如果根据现有的正面和负面证据的权重,递延所得税资产的一部分或全部很可能无法实现,则提供估值备抵以减少所报告的递延所得税资产。
ASC主题740.10.30澄清了企业财务报表中确认的所得税不确定性的会计处理,并规定了财务报表中确认和计量纳税申报表中已采取或预期将采取的税务状况的确认门槛和计量属性。ASC主题740.10.40提供了关于终止确认、分类、利息和罚款、中期会计、披露和过渡的指导。
最近颁布和采用的会计准则
财务会计准则委员会或其他标准制定机构不时发布新的会计公告,这些公告可能会对GIO的会计和报告产生影响。GIO认为,这些最近发布的会计公告和其他权威性指导意见的生效日期在未来,要么不会对GIO的会计或报告产生影响,要么在实施时不会对GIO的财务状况、业务结果和现金流量产生重大影响。
235
MANAGEMENT OF THE COMBINED COMPANY FLLOWING THE BUSINESS COMBINATION
业务合并后的执行干事和董事
合并后,合并公司的业务和事务将由合并公司董事会管理或在合并公司董事会的指导下管理。下表列出了在业务合并完成后预计将担任合并后公司董事、执行干事或关键雇员的个人的姓名、截至2023年[·]的年龄和职位:
姓名 |
|
年龄 |
|
职位) |
Anand Srivastava博士 |
57 |
董事长兼首席科学官 |
||
德文·帕特尔 |
52 |
首席执行官兼董事 |
||
[•] |
[·] |
首席财务官 |
||
Joel Shulman |
56 |
独立董事 |
||
[•] |
[·] |
独立董事 |
||
[•] |
[·] |
独立董事 |
||
[•] |
[·] |
独立董事 |
执行干事
阿南德·斯里瓦斯塔瓦博士是GIO的首席科学官。他目前还是GIOSTAR的联合创始人、董事长和首席科学官,GIOSTAR是一个隶属于GIO的实体,自2008年以来一直担任这一职务。在他的职业生涯中,斯里瓦斯塔瓦博士与美国的主要大学有联系,并在这些大学进行研究,包括加州大学圣迭戈分校、加州大学欧文医学院、索尔克生物学研究所、桑福德·伯纳姆·普雷比斯医学发现研究所和加州大学洛杉矶医学院。斯里瓦斯塔瓦博士的研究成果发表在同行评议的科学期刊上,并在印度、日本、德国和美国的各种国家和国际科学会议上发表。2020年,美国亚洲癌症研究科学家协会表彰了斯里瓦斯塔瓦博士在癌症研究领域的贡献。最近,斯里瓦斯塔瓦博士获得了泰国国家建筑研究所颁发的“2022年世界移位者奖”。Srivastava博士在Banaras印度教大学获得了硕士和博士学位。
德文•帕特尔是GIO的首席执行官。他目前还是GIOSTAR的联合创始人、总裁兼首席执行官,GIOSTAR是一家隶属于GIO的实体,自2008年以来一直担任该职位。帕特尔先生在干细胞领域拥有超过15年的经验,他曾与政府和医疗保健提供者合作,与GIOSTAR及其附属机构建立干细胞相关项目。2011年,帕特尔因其在传播干细胞科学进步方面所做的努力而获得了美国国会的表彰。帕特尔先生于2011年担任圣地亚哥印第安人协会联合会主席。帕特尔还曾在GIOSTAR基金会、亚太裔美国人联盟(APAC)、圣地亚哥亚洲商业协会和现实改变者等多个组织担任要职。帕特尔于2015年7月申请第7章破产保护,并于2015年10月被解除破产程序。帕特尔在伊利诺伊大学芝加哥分校获得学士学位。
独立董事
以下对合并后公司预期独立董事的经历的描述不包括对Joel Shulman和[ • ]的描述,这两个人在本委托书/招股说明书中的标题为“公司合并前ACIC的董事、高级管理人员、高管薪酬和公司治理”的部分。
乔尔·M·舒尔曼是ACIC的首席执行官兼董事会主席。他还担任ERShares的创始人、董事总经理和首席信息官。ERShares是一家全球资产管理公司,拥有40多年投资创业上市公司的经验。他在巴布森学院从事了超过25年的研究,并著有一本在哈佛大学期间开发的畅销书,导致了专有投资模型和企业家因素的形成。舒尔曼博士之前创立并出售了《舒尔曼评论》,这是一家CFA的备考公司,在世界各地的许多国家培训了数千名投资专业人士。他为世界银行提供咨询服务,并帮助促进中亚国家资本市场的发展。舒尔曼经常出现在福克斯商业频道、CNBC、雅虎财经、彭博、《华尔街日报》、《巴伦周刊》和《福布斯》的媒体上。他拥有哈佛大学金融学博士学位、CFA特许持有人和MPA学位。舒尔曼博士因其重要的领导能力和财务经验而被选入合并后公司的董事会。
236
合并后的公司董事会组成
根据《企业合并协议》,在企业合并后立即生效,除Joel Shulman外,ACIC的所有现任董事都将辞职,不再担任合并后公司董事会成员。
如果拟议章程获得批准,在业务合并完成后,合并公司董事会将由七名董事组成,每名董事在合并公司董事会任职,任期交错三年,或直至其继任者当选并获得资格,或直至其去世、辞职或被免职(以较早者为准)。
业务合并完成后生效的拟议章程规定,只有合并后的公司董事会才能填补空缺的董事职位,包括新设立的席位。
董事独立性
合并后的公司预计,合并后的公司董事会中除Patel先生、Srivastava博士和[ • ]之外的每一位成员都将符合证券交易委员会规则和条例要求的独立资格。
委员会对风险的监督
业务合并完成后,合并公司董事会的主要职能之一将是对合并公司的风险管理过程进行知情监督。合并公司董事会并不预期会有一个常设风险管理委员会,而是预期会通过整个合并公司董事会以及通过合并公司董事会的各个常设委员会直接管理这一监督职能,这些委员会处理各自监督领域的固有风险。例如,合并公司审计委员会将负责监督与合并公司财务报告、会计和审计事项相关的风险管理,合并公司薪酬委员会将监督与合并公司薪酬政策和方案相关的风险管理。
合并公司董事会委员会
合并后的公司董事会将按照特拉华州法律的规定指导其业务和事务的管理,并将通过董事会和常设委员会会议处理其业务。合并后的公司将设立一个常设审计委员会、薪酬委员会、提名和公司治理委员会,每个委员会都将根据一份书面章程运作。合并后,合并公司委员会章程的现有副本将在其网站上公布,[·]。
237
审计委员会
合并完成后,合并后公司审计委员会的成员将分别为[·]和[·],他们都能阅读和理解基本财务报表。根据美国证券交易委员会的规则和条例以及适用于审计委员会成员的OTCM的上市规则,[·]和[·]中的每一个都是独立的。[·]将担任审计委员会主席。[·]符合SEC法规所指的审计委员会财务专家资格,并符合OTCM的财务复杂程度要求。合并后公司的审计委员会将协助合并后公司董事会监督以下事项:合并后公司财务报表的完整性;合并后公司遵守法律和监管规定的情况;独立注册会计师事务所的资格、独立性和业绩;合并后公司内部审计职能的设计和实施以及风险评估和风险管理。除其他事项外,合并后公司的审计委员会将负责审查并与合并后公司的管理层讨论合并后公司的披露控制和程序的充分性和有效性。审计委员会还将与合并公司管理层和独立注册会计师事务所讨论年度审计计划和审计活动范围、合并公司财务报表年度审计的范围和时间安排、审计结果、合并公司财务报表季度审查,并将酌情对合并公司财务事务的某些方面展开调查。合并后公司的审计委员会将负责制定和监督程序,以接收、保留和处理有关会计、内部会计控制或审计事项的任何投诉,以及合并后公司的雇员就可疑的会计或审计事项提出的保密和匿名意见。此外,合并后公司的审计委员会将直接负责合并后公司独立注册会计师事务所的任命、报酬、留用和监督工作。合并后公司的审计委员会将拥有批准合并后公司独立注册会计师事务所的聘用和离职、所有审计聘用条款和费用以及与独立审计员进行的所有允许的非审计聘用的唯一权力。合并后公司的审计委员会将根据合并后公司的政策和程序,审查和监督所有关联交易。
薪酬委员会
合并完成后,合并后公司薪酬委员会的成员为[·]和[·]。[·]将担任薪酬委员会主席。根据美国证交会的规则和条例,以及适用于薪酬委员会成员的OTCM上市规则,合并后公司薪酬委员会的每个成员都将被视为独立的。合并后公司的薪酬委员会将协助合并后公司董事会履行合并后公司的某些责任,包括补偿其执行人员,管理和审查其对雇员和其他服务提供者的激励计划,包括其股权激励计划,以及与合并后公司的薪酬计划有关的某些其他事项。
提名和公司治理委员会
合并完成后,合并后公司的提名和公司治理委员会成员将为[·]和[·]。[·]将担任提名和公司治理委员会主席。合并后公司的提名和公司治理委员会将协助合并后公司董事会按照合并后公司董事会批准的标准,监督和确定有资格成为合并后公司董事会成员的个人,并选择或建议合并后公司董事会选择董事提名人选,制定并向合并后公司董事会推荐一套公司治理准则,并监督对合并后公司董事会的评估。
238
行为守则
业务合并完成后,合并后的公司董事会将通过一项行为守则。《行为守则》将适用于合并后公司的所有雇员、管理人员和董事,以及合并后公司的所有承包商、顾问、供应商和与其在合并后公司的工作有关的代理人。合并完成后,合并后公司的《行为守则》全文将公布在合并后公司的网站[·]上。合并后的公司打算根据美国证券交易委员会的规定,在上述合并后公司网站的同一地点或公开文件中披露未来对合并后公司行为准则的修订或豁免。合并后公司网站上所载的信息并未通过引用并入本代理声明/招股说明书,您不应将合并后公司网站上所载的信息视为本代理声明/招股说明书的一部分。
薪酬委员会的联锁及内部人士的参与
合并后公司薪酬委员会的拟任成员中,没有一人曾经是任何其他实体的董事会或薪酬委员会的成员,而任何其他实体的董事会或薪酬委员会中有或曾经有一名或多名执行干事担任合并后公司董事会或薪酬委员会的成员。
239
行政补偿
ACIC高管薪酬
我们没有任何人员因向我们提供服务而获得任何现金补偿。我们每月向赞助者支付共计10000美元,用于办公空间、水电费以及秘书和行政支助。一旦我们的初始业务合并或清算完成,我们将停止支付这些月费。在完成我们的初始业务合并之前,或与为完成我们的初始业务合并而提供的任何服务有关,我们不会向我们的保荐人、高级职员和董事或我们的保荐人或高级职员的任何关联机构支付任何形式的补偿,包括任何发现者费用、补偿或咨询费(无论交易类型如何)。然而,这些个人将得到补偿,用于支付与代表我们开展的活动有关的任何自付费用,例如确定潜在的目标企业和对适当的企业合并进行尽职调查。我们没有一项政策禁止我们的保荐人、执行人员或董事,或他们各自的任何关联公司,就目标企业的自付费用补偿进行谈判。我们的审计委员会每季度审查向我们的保荐人、高级职员或董事、或我们或他们的关联公司支付的所有款项。在初始业务合并之前,任何此类付款都将使用信托账户以外的资金。除了每季度审计委员会审查这些付款外,我们预计不会有任何额外的控制措施来管理我们对董事和执行干事的补偿付款,以支付他们在确定和完成初始业务组合方面的自付费用。
在我们的初始业务合并完成后,留在我们公司的董事或管理团队成员可能会从合并后的公司获得咨询费或管理费。所有这些费用将在已知的范围内,在向我们的股东提供的与拟议的初始业务合并有关的要约收购材料或代理招标材料中向股东充分披露。我们没有对合并后的公司向我们的董事或管理层成员支付的此类费用的金额设置任何限制。在拟议的初始业务合并时不太可能知道这种补偿的数额,因为合并后业务的董事将负责确定高级职员和董事的补偿。支付给高级职员的任何薪酬将由一个完全由独立董事组成的薪酬委员会或由我们董事会的多数独立董事决定,或建议董事会决定。
我们不打算采取任何行动来确保我们的管理团队成员在我们的初始业务合并完成后保持他们在我们的职位,尽管我们的一些或所有管理人员和董事可能会在我们的初始业务合并后谈判雇佣或咨询安排以留在我们。为保留他们在我们的职位而作出的任何此类雇用或咨询安排的存在或条款可能会影响我们的管理层确定或选择目标企业的动机,但我们不认为我们的管理层在完成我们的初始业务合并后继续留在我们身边的能力将是我们决定进行任何潜在业务合并的决定性因素。我们没有与我们的高级职员和董事签订任何在终止雇佣关系时提供福利的协议。
GIO执行干事薪酬
在截至2022年12月31日的财政年度,GIO没有雇员,也没有向任何执行官员支付任何报酬或作出任何股权奖励。
企业合并后公司高管薪酬和协议
合并后,合并后的公司打算采用一项高管薪酬方案,旨在使薪酬与合并后公司的业务目标和创造股东价值保持一致,同时使合并后的公司能够吸引、激励和留住对合并后公司的长期成功作出贡献的个人。该计划将由合并公司董事会的薪酬委员会管理。
在交割时,合并后的公司将与Patel先生和Srivastava博士签订与类似情况公司的执行安排相一致的基于市场的雇佣协议。这些雇佣协议的重要条款载于“合并后公司的管理——高管薪酬安排”。
240
股权激励计划
关于企业合并,ACIC打算采用激励计划,但须经ACIC股东批准。如果获得通过和核准,奖励计划将在结束时生效。激励计划提案在随附的委托书/招股说明书的标题“提案10:激励计划提案”下有更详细的描述。
董事薪酬
在截至2022年12月31日的财政年度,GIO没有向任何董事支付任何补偿或股权奖励。出于这个原因,GIO省略了2022年董事薪酬表和相应的叙述性披露。
业务合并后公司董事薪酬
合并后的公司打算制定一个非雇员董事薪酬方案,旨在使薪酬与合并后公司的业务目标保持一致,同时使合并后的公司能够吸引和留住有助于其长期成功的个人进入合并后的公司董事会。
241
某些关系及有关人士的交易
ACIC关联方交易
2021年2月5日,我们的保荐人购买了5,750,000股创始人股票,总购买价为25,000美元,约合每股0.006美元(调整后反映了2021年8月返还的1,437,500股创始人股票),以支付我们的某些发行成本。2021年8月,我们的保荐人免费退还了我们注销的1,437,500股创始人股份,导致我们的保荐人持有的4,312,500股创始人股份。在承销商的超额配股权未全部或部分行使的情况下,创始人股份包括可被保荐人没收的合计562,500股股份,因此在转换后,保荐人将合计拥有公司在首次公开发行后已发行和已发行股份的20%。由于承销商在首次公开发行时充分行使了超额配股权,没有任何方正股份可被没收。除某些有限的例外情况外,创始人股份(包括可在行使时发行的A类普通股)不得由持有人转让、转让或出售。
我们的保荐人和Cantor以每份认股权证1.00美元的价格(总计8200000美元)购买了总计8200000份私募认股权证,这是在我们首次公开发行结束的同时进行的,产生了8200000美元的总收益。每份私募认股权证的持有者有权以每股11.50美元的价格购买一股我们的A类普通股。除某些有限的例外情况外,私人认股权证(包括在行使认股权证时可发行的A类普通股)不得由持有人转让、转让或出售,直至我们的初始业务合并完成后30天。
如果我们的任何高级职员或董事意识到一个初始业务合并机会,该机会属于他或她当时负有受托或合同义务的任何实体的业务范围内,他或她将履行他或她的受托或合同义务,向该其他实体提供此类业务合并机会。我们的管理人员和董事目前负有某些相关的受托责任或合同义务,这些义务可能优先于他们对我们的责任。
我们每月向赞助者支付共计10000美元,用于办公空间、水电费以及秘书和行政支助。一旦我们的初始业务合并或清算完成,我们将停止支付这些月费。
除上述情况外,我们不会在完成初始业务合并之前,或与为完成初始业务合并而提供的任何服务有关的情况下,向我们的保荐人、高级职员和董事或我们的保荐人或高级职员的任何关联机构支付任何形式的补偿,包括任何发现者的费用、补偿、咨询费或与任何贷款支付有关的款项(无论交易类型如何)。然而,这些个人将得到补偿,用于支付与代表我们开展的活动有关的任何自付费用,例如确定潜在的目标企业和对适当的企业合并进行尽职调查。我们没有一项政策禁止我们的保荐人、执行人员或董事,或他们各自的任何关联公司,就目标企业的自付费用补偿进行谈判。我们的审计委员会将每季度审查向我们的赞助商、高级职员、董事或我们或他们的附属公司支付的所有款项,并将决定哪些费用和费用的偿还金额。对这些人因代表我们开展的活动而自付费用的偿还没有上限或上限。
2021年2月5日,保荐人向本公司发行了一张无担保本票(经修订的“本票”),据此,本公司可借入本金总额不超过300,000美元的款项。本票不计息,应于2022年3月31日或首次公开发行完成时支付,以较早者为准。本票已于2021年11月12日首次公开发行结束时全额偿还。此外,为了支付与预期的初始业务合并有关的交易费用,我们的保荐人或我们的保荐人的关联公司或我们的某些高级职员和董事可以(但无义务)在可能需要的无息基础上向我们提供贷款。如果我们完成初始业务合并,我们将偿还这些贷款。如果最初的业务合并没有结束,我们可以使用信托账户以外的部分周转资金来偿还这些贷款,但我们的信托账户的收益不会用于偿还。根据贷款人的选择,这种贷款中最多可有1500000美元可兑换成认股权证,每份认股权证的价格为1.00美元。认股权证将与私募认股权证相同,包括行使价格、行权性和行权期。我们预期不会向除我们的保荐人或保荐人的附属公司以外的其他方寻求贷款,因为我们不相信第三方会愿意借出这些资金,并放弃任何及所有寻求获得我们信托账户资金的权利。
2023年4月5日,我们向保荐人的关联公司SIA Ventures,LLC发行了本金不超过25万美元的本票(“本票”)。该票据是就SIA Ventures,LLC未来可能向我们提供的预付款发出的。
242
营运资本支出。该票据不计利息,应在(a)初始业务合并完成时或(b)我们清算之日到期并支付。
在我们最初的业务合并后,我们的管理团队成员如果留在我们公司,可能会从合并后的公司获得咨询、管理或其他费用,任何和所有的金额都将在当时已知的范围内,在向我们的股东提供的要约收购或代理招标材料(如适用)中向我们的股东充分披露。在分发这类要约材料时,或在召开股东大会审议我们的初始业务合并(视情况而定)时,不太可能知道这类补偿的金额,因为这将由合并后业务的董事决定执行和董事的补偿。
我们已就私募认股权证、可在营运资金贷款转换时发行的认股权证(如有的话)以及可在行使上述规定和转换创始人股份时发行的A类普通股订立登记和股东权利协议。
此外,只要私人认股权证是由Cantor或其指定人士或附属公司持有,这些认股权证将受FINRA规则第5110条规定的锁定期和登记权限制,并且在我们的首次公开发行开始销售后五年内不得行使。
GIO关联方交易
GIO是否能够成功地或完全地开展这些业务,取决于Srivastava博士和Patel先生将与干细胞相关的商业秘密、专有技术和知识产权独家转让给GIOSTAR。GIOSTAR是由Srivastava博士和Patel先生控制并拥有多数股权的实体,而GIOSTAR又授予了独家许可(在有限的例外情况下),可以在属于GIO四个业务线的活动中使用此类商业秘密、专有技术和知识产权。根据这种安排,GIOSTAR可将这些商业秘密、专门知识和知识产权用于业务线以外的目的,或继续在哥斯达黎加、墨西哥和印度这三个国家拥有和经营抗衰老诊所,在这些国家,GIO将不享有从事这一业务线的专属权利。此外,除非GIO能够为化妆品或其他产品制造AHSDM或其他“活性成分”,否则GIO预计将依赖根据GIOSTAR供应协议向GIO交付的AHSDM来启动和制定此类业务计划。如果GIOSTAR出于任何原因不履行或遵守GIOSTAR许可协议和排他性协议的条款,或Srivastava博士或Patel先生未能使GIOSTAR完全满足上述任何安排的条款和要求,包括在GIOSTAR和GIO或Srivastava博士和Patel先生的商业利益与GIO的商业利益发生冲突时,GIO的业务和未来的招股说明书将受到重大不利影响。
在执行业务合并协议的同时,某些GIO卖方与ACIC和GIO签订了投票协议。有关更多信息,请参阅本代理声明/招股说明书中的“提案1 ——企业合并提案——投票协议”。
在执行《业务合并协议》的同时或在完成交割时,(i)在紧接生效时间之前拥有GIO已发行和未发行股份98.703%以上的GIO股东与合并后的公司和买方代表签订了锁定协议。有关更多信息,请参阅本代理声明/说明书中的“建议1:业务合并建议——锁定协议”。
业务合并后的关联人交易政策
自业务合并完成后,合并后的公司董事会将采用书面的关联人交易政策,其中将规定审查、批准或批准关联人交易的以下政策和程序。
243
“关联人交易”是指合并后的公司或其任何子公司过去、现在或将来都是参与者的交易、安排或关系,所涉金额超过120,000美元,任何关联人在其中拥有、拥有或将拥有直接或间接的重大利益。“关联人”是指:
| ● | 任何在适用期间内或在任何时间曾是合并公司的一名行政人员或合并公司的一名董事的人; |
| ● | 合并公司所知的拥有合并公司5%以上有表决权股份的实益拥有人; |
| ● | 任何上述人士的直系亲属,指董事、行政人员或合并后公司5%以上有表决权股份的实益拥有人的任何子女、继子女、父母、继父母、配偶、兄弟姐妹、岳母、岳父、女婿、儿媳、姐夫或弟媳,以及与该董事、行政人员或合并后公司5%以上有表决权股份的实益拥有人同住的任何人(租户或雇员除外);及 |
| ● | 任何公司、法团或其他实体,而上述任何人是合伙人或委托人,或处于类似地位,或该人拥有10%或以上的实益所有权权益。 |
合并后的公司将制定政策和程序,尽量减少与其附属公司的任何交易可能产生的潜在利益冲突,并为披露可能不时存在的任何实际或潜在利益冲突提供适当的程序。具体而言,根据合并后公司的审计委员会章程,审计委员会将负责审查关联方交易。
244
证券的受益所有权
下表及随附的脚注列出了以下信息:(一)截至2023年3月31日,在企业合并之前,ACIC的实益所有权;以及(二)在企业合并完成之后,合并后的公司的实益所有权,假设没有公众股份被赎回(“没有赎回”),或者,326,881股公众股份被赎回与企业合并有关(“BCA最大赎回”):
| ● | ACIC所知在该日期是合并公司普通股5%以上股份的实益拥有人的每一人; |
| ● | ACIC的每一位现任执行官和ACIC董事会的每一位成员,以及ACIC的所有执行官和董事作为一个整体; |
| ● | 交易完成后将成为合并后公司的行政人员或董事的每一人,以及所有这些行政人员和董事作为一个整体;和 |
| ● | 所有这些行政人员和官员作为一个群体。 |
受益人所有权是根据证交会的规则确定的,该规则一般规定,如果一个人拥有对该证券的单独或共同投票权或投资权,包括目前可行使或可在60天内行使的期权和认股权证,他就拥有该证券的受益人所有权。除下文脚注中所述的情况外,并受适用的共有财产法和类似法律的约束,我们认为上述每一个人对这些股份拥有唯一的投票权和投资权。
合并前普通股的实益所有权基于截至2023年3月31日已发行和流通的4312500股ACIC普通股。
在企业合并完成后,合并后公司普通股股份的预期实益所有权假设两种情形:
| ● | 假设没有赎回:本演示文稿假定,在企业合并完成后,ACIC的任何公众股东均不对其公众股份行使赎回权。 |
| ● | 假设BCA最大赎回:这一列报假定:(一)326881股公众股赎回,赎回付款总额为340万美元,假定根据截至2023年4月30日信托账户的资金计算的每股赎回价格为10.47美元;(二)如果ACIC在收盘时没有现金或现金等价物,拟议的业务合并将不会完成,包括信托账户中的剩余资金(在完成和支付赎回款项后)和任何交易融资的收益,至少相当于在交易结束时支付ACIC和GIO的估计交易费用和负债所需的数额费用条件,”如下文进一步描述)。由于ACIC的所有Insiders在ACIC IPO时都放弃了赎回权,本演示文稿中只反映了公众股东的赎回。这一设想方案包括“无赎回”设想方案中所载的所有调整,并提出额外的调整,以反映《巴塞尔公约》最大赎回的影响,同时考虑到费用条件。“BCA最大赎回情形”(i)假设NTA提案在特别会议上获得ACIC股东的批准,并且(ii)代表在满足费用条件的情况下可赎回的最大公众股份数量;但是,前提是根据业务合并协议的条款,费用条件不是完成交易的合同条件,并且业务合并可以在不满足费用条件的情况下按照合同交易条款完成。如果企业合并在费用条件未得到满足的情况下完成(或者,如果估计的交易费用或任何交易融资的收益(如果有的话)导致在截止日期的费用条件与本BCA最大赎回情景演示文稿中包含的假设不同),最多可赎回“BCA最大赎回情景”中所反映的1175322股公众股票。 |
这两种情形都假定,在企业合并完成之前,已发行和未发行的ACIC普通股总数为5814703股,在企业合并完成后,这些股份将被交换为合并后公司的普通股。
245
这两种情形都假设,在收盘时,根据截至2022年12月31日在完全稀释和转换基础上已发行的GIO普通股的数量,估计将向GIO卖方发行23,568,155股合并后公司普通股,并假设在收盘时或之前,公司已进行了交易。这一估计股份数目不包括在收盘后满足适用的盈利条款后可向盈利卖方发行的潜在54,000,000股盈利股票。
基于上述假设,我们估计在“不赎回”情形下,在企业合并完成后立即发行和流通的合并后公司普通股为29,382,858股,在“最大赎回”情形下,在企业合并完成后立即发行和流通的合并后公司普通股为29,055,977股。如果实际事实与这些假设(它们很可能是)不同,ACIC股东保留的所有权百分比将有所不同。见“股份计算和所有权百分比”和“未经审计的简明合并财务报表”。
除非在下表脚注中另有说明,并在符合适用的共有财产法的前提下,表中所列个人和实体对其实益拥有的证券拥有唯一的投票权和投资权。除表格脚注所示外,以下所列的每一证券持有人对这些股东所拥有的普通股或合并公司普通股拥有唯一的投票权和投资权。
业务合并前受益所有权表
A类普通股 |
B类普通股 |
近似 |
|||||||||
数目 |
数目 |
百分比 |
|||||||||
股票 |
近似 |
股票 |
近似 |
杰出 |
|
||||||
|
有益的 |
|
百分比 |
|
有益的 |
|
百分比 |
|
共同 |
||
实益拥有人的姓名及地址(1) |
拥有 |
类 |
拥有 |
类 |
股票 |
||||||
Apeiron Capital赞助商有限责任公司(2) |
— |
— |
4,312,500 |
100 |
% |
74.2 |
% |
||||
Joel Shulman(3) |
— |
— |
4,312,500 |
100 |
% |
74.2 |
% |
||||
Eva Adosoglou(3) |
— |
— |
— |
— |
— |
||||||
Grant Grigorian(3) |
— |
— |
— |
— |
— |
||||||
Kevin Cramton(3) |
— |
— |
— |
— |
— |
||||||
查尔斯·阿古拉斯(3) |
— |
— |
— |
— |
— |
||||||
Jeffrey Mortimer(3) |
— |
— |
— |
— |
— |
||||||
所有执行干事和主任作为一个群体(六人)(3) |
— |
— |
4,312,500 |
100 |
% |
74.2 |
% |
||||
其他5%股东 |
— |
— |
— |
— |
— |
||||||
Spring Creek Capital,LLC(4) |
200,000 |
13.3 |
% |
— |
— |
3.4 |
% |
||||
Castle Creek套利有限责任公司(5) |
125,300 |
8.3 |
% |
— |
— |
2.2 |
% |
||||
AQR套利有限责任公司(6) |
91,007 |
6.1 |
% |
— |
— |
1.6 |
% |
||||
(1) |
除非另有说明,下列各实体或个人的营业地址为c/o 175 Federal Street,Suite 875,Boston,MA 02110。 |
(2) |
我们的保荐人是此类股份的记录持有人。我们的赞助商是由我们的首席执行官Joel Shulman控制的。因此,他对我们的保荐人所持有的记录在案的普通股拥有投票权和投资自由裁量权,并可能被视为对我们的保荐人直接持有的普通股拥有实益所有权。 |
(3) |
这些人中的每一个人都在我们的赞助商中拥有直接或间接的权益。除直接或间接在所报告的股份中可能拥有的任何金钱利益外,每一此种人均放弃对所报告的股份的任何实益所有权。 |
(4) |
根据Spring Creek Capital,LLC(“Spring Creek”)、SCC Holdings,LLC、KIM,LLC、Koch Investments Group,LLC、Koch Investments Group Holdings,LLC和Koch Industries(与Spring Creek合称“Koch各方”)于2023年2月10日向SEC提交的附表13G,Spring Creek拥有20万股。Koch Party的主要营业地址是4111 E. 37th Street North,Wichita,KS 67220。 |
(5) |
根据2023年2月13日Castle Creek Arbitrage,LLC(“Castle Creek”)、Allan Weine先生、CC ARB West,LLC(“ARB West”)和CC Arbitrage,Ltd.(“CC Arbitrage”)提交给SEC的附表13G,Weine先生与Castle Creek |
246
(一)ARB西部拥有的120,000股和(二)CC Arbitrage拥有的5,300股。CC缔约方的主要营业地址是111 W. Beaver Creek Blvd PO Box 3500 Avon,CO 81620。
(6) |
根据AQR Capital Management,LLC(“AQR Capital Management”)、AQR Capital Management Holdings,LLC(“AQR Capital Holdings”)和AQR Arbitrage,LLC(“AQR Arbitrage”)以及AQR Capital Management和ACQ Capital Holdings(“AQR各方”)于2023年2月14日向SEC提交的附表13G,AQR Arbitrage拥有91,007股股份。AQR缔约方的主要营业地址是格林威治广场一号,电话:CT06830。 |
业务后合并受益所有权表
合并公司业务后合并 |
|||||||||
(假设没有 |
(假设BCA |
||||||||
实益拥有人的姓名及地址(1) |
|
数目 |
|
% |
|
数目 |
|
% |
|
保荐人、董事和执行干事的业务后组合: |
|||||||||
GIOSTAR |
15,818,553 |
53.84 |
% |
15,818,553 |
54.44 |
% |
|||
Apeiron Capital赞助商有限责任公司 |
4,312,500 |
14.68 |
% |
4,312,500 |
14.84 |
% |
|||
Joel Shulman(3) |
4,312,500 |
14.68 |
% |
4,312,500 |
14.84 |
% |
|||
Anand Srivastava博士 |
1,767,956 |
6.02 |
% |
1,767,956 |
6.08 |
% |
|||
德文·帕特尔 |
1,767,956 |
6.02 |
% |
1,767,956 |
6.08 |
% |
|||
合并后公司的所有董事和执行干事作为一个集团进行业务合并(3人) |
23,666,965 |
80.55 |
% |
23,666,965 |
81.45 |
% |
|||
5%持有者: |
|||||||||
TAG合作伙伴 |
2,493,666 |
8.49 |
% |
2,493,666 |
8.58 |
% |
|||
(1) |
除非另有说明,下列各实体或个人的营业地址为c/o 175 Federal Street,Suite 875,Boston,MA 02110。 |
(2) |
Srivastava博士和Patel先生对全球干细胞治疗和研究研究所持有的ACIC普通股股份行使投票权和投资控制权。 |
(3) |
保荐人由Joel Shulman控制,因此,他对保荐人记录在案的普通股股份拥有投票权和投资自由裁量权,并可被视为拥有这些股份的共同实益所有权。 |
247
合并公司证券说明
合并完成时合并后公司证券的说明
以下对合并后公司证券的重要条款的概述并不是对这些证券的权利和优惠的完整概述。以下说明以《拟议宪章》的实际案文为限,我们促请你阅读作为本代理声明/说明书附件B所附的《拟议宪章》全文。《宪章提案》在《第3号提案:宪章提案》中作了概述。
普通股
根据拟议的章程,企业合并完成后,合并后公司的法定股本将包括500,000,000股合并后公司普通股,每股面值0.0001美元和5,000,000股非指定优先股,每股面值0.0001美元。
投票权
合并后,合并后的公司普通股的每一股将有权对所有提交股东表决的事项投一票。
合并后的公司并没有在拟议的章程中为董事选举规定累积投票。因此,持有合并后公司普通股当时已发行股份的多数投票权,有权在选举董事时投票,作为一个单一类别共同投票,将能够选举合并后公司的所有董事。
股息权
根据可能适用于当时发行在外的任何优先股的优惠,合并公司普通股的持有者有权根据合并公司董事会可能决定的时间和数额,获得合并公司酌情决定的股息。每一类合并公司普通股的股票红利只能用同一类普通股的股票支付。
无优先购买权或类似权利
合并后公司普通股的持有者将无权享有优先购买权,他们的股份将不受赎回或偿债基金条款的约束。
获得清算分配的权利
合并后的公司在清算、解散或清盘时,可合法分配给合并后公司股东的资产将按照合并后公司普通股持有人持有的合并后公司普通股的股份数量,按比例分配给合并后公司普通股持有人,但须事先清偿所有未清偿的债务和债务,以及优先股的优先权和清算优先权的支付(如果有的话)。
248
优先股
拟议章程规定,优先股可不时以一个或多个系列发行。我们的董事会将被授权确定适用于每一系列股票的投票权(如果有)、指定、权力、优先权、相对权利、参与权利、选择权或其他特殊权利及其任何资格、限制和限制。我们的董事会将能够在没有股东批准的情况下,发行具有投票权和其他权利的优先股,这可能会对合并后公司普通股股东的投票权和其他权利产生不利影响,并可能产生反收购影响。我们的董事会在没有股东批准的情况下发行优先股的能力,可能会延迟、推迟或阻止我们控制权的变更或现有管理层的撤换。在此日期,我们没有发行在外的优先股。虽然我们目前不打算发行任何优先股,但我们不能向你保证我们将来不会这样做。在企业合并中没有发行或登记优先股。
我们的转让代理和授权代理
我们的普通股转让代理和我们的认股权证代理是大陆股票转让和信托公司,一道富,30楼,纽约,纽约10004。
证券上市
合并后的公司拟申请将其股票和认股权证在OTCM或全国性证券交易所上市,股票代码分别为“[·]”和“[·]”。普通股在OTCM或国家证券交易所上市是收盘的条件。无法保证合并后的公司将能够满足初始上市要求或在业务合并完成后继续上市的要求。
企业合并前ACIC证券的说明
概述
ACIC单位
每个单位由一股普通股和一份可赎回认股权证的一半组成。每一整份认股权证赋予持有人购买一股普通股的权利。每份可赎回认股权证的持有人有权以每股11.50美元的价格购买一股普通股,但须按本招股说明书所述进行调整。根据《认股权证协议》,认股权证持有人只可就全部股份行使其认股权证。这意味着在任何给定的时间,权证持有人只能行使整个权证。普通股和认股权证分别于2021年12月30日开始交易。
普通股
我们的登记在册的股东有权就所有有待股东投票的事项每持有一股一票。就批准我们的首次业务合并所举行的任何表决而言,保荐人以及我们的所有高级职员和董事已同意,在首次公开发行前,以及在首次公开发行中或首次公开发行后在公开市场上购买的任何股份,对他们各自拥有的普通股股份投票赞成拟议的业务合并。
我们将完成我们的初始业务合并,如果投票批准业务合并,并且大多数普通股投票赞成业务合并。
我们的董事会分为三个级别,每个级别的任期一般为三年,每年只选出一个级别的董事。董事选举不实行累积投票,结果是有资格投票选举董事的股份超过50%的股东可以选举所有董事。
根据我们的现行章程,如果我们不能在2023年8月14日之前完成初始业务合并,我们的公司将停止存在,除非是为了结束我们的事务和清算。如果我们被迫在初始业务合并之前进行清算,我们的公众股东有权根据信托账户中当时持有的金额,按比例分享信托账户中的份额。
249
保荐人、高级管理人员和董事已同意放弃参与任何清算分配的权利,这些清算分配发生在我们未能完成有关创始人股份的初始业务合并时。因此,我们的保荐人、管理人员和董事将不会参与信托账户中有关此类股份的任何清算分配。然而,他们将参与信托账户对在首次公开发行期间或之后获得的任何普通股股份的任何清算分配。
我们的股东没有转换、优先认购权或其他认购权,也没有适用于普通股股份的偿债基金或赎回条款,但公众股东有权以要约方式将其股份出售给我们,或在完成我们的业务合并时将其普通股股份转换为与其在信托账户中的比例相等的现金。出售股票或将其转换为信托账户份额的公共股东仍有权行使其作为单位一部分收到的认股权证。
优先股
没有发行在外的优先股。我们的现行章程授权发行1,000,000股优先股,其名称、权利和优惠由我们的董事会不时决定。首次公开发行中没有发行或登记优先股。因此,我们的董事会有权在没有股东批准的情况下,发行具有股息、清算、转换、投票或其他权利的优先股,这些权利可能会对普通股股东的投票权或其他权利产生不利影响。然而,承销协议禁止我们在企业合并之前发行以任何方式参与信托账户收益的优先股,或在企业合并时与普通股作为一个类别投票的优先股。我们可能会发行部分或全部优先股,以实现业务合并。此外,优先股可以用作阻止、延迟或阻止我们控制权变更的一种方法。虽然我们目前不打算发行任何优先股,但我们不能向你保证我们将来不会这样做。
认股权证
每份整份认股权证使登记持有人有权以每股11.50美元的价格购买一股普通股,但须按下文所述的调整,在初始业务合并完成后30天或首次公开发行结束后12个月(以较晚者为准)开始的任何时间进行。然而,任何认股权证都不能以现金形式行使,除非我们有一份有效和现行的登记声明,涵盖在行使认股权证时可发行的普通股股份,以及一份与这些普通股股份有关的现行招股说明书。尽管如此,如果一份涵盖在行使公开认股权证时可发行的普通股股份的登记声明在我们的初始业务合并完成后的指定期间内不有效,认股权证持有人可以根据《证券法》第3(a)(9)条规定的豁免在无现金基础上行使认股权证,直至有一份有效的登记声明为止,并且在我们未能保留有效登记声明的任何期间内,只要这种豁免是可用的。如果不能获得这一豁免或另一项豁免,持有者将无法在无现金的基础上行使其认股权证。在这种无现金行使的情况下,每个持有者将通过放弃认股权证来支付行使价格,该认股权证的数量相当于认股权证的普通股数量除以(x)认股权证的基础普通股数量乘以认股权证的行使价格与“公平市场价值”(定义见下文)之间的差额乘以(y)公平市场价值所得到的商。为此目的,“公允市场价值”指的是在行使之日前一个交易日结束的十个交易日内,普通股股票的平均最后一次出售价格。认股权证将在我们完成首次业务合并的第五个周年纪念日,即纽约市时间下午5:00到期,或在赎回或清算时提前到期。
私人认股权证,以及我们向保荐人、高级职员、董事或他们的关联公司发行的任何额外认股权证,以支付向我们提供的营运资金贷款,将与本招股说明书所提供的单位的相关认股权证相同,但此类认股权证可根据持有人的选择以现金或无现金方式行使,并且不能由我们赎回,在每种情况下,只要它们仍由保荐人或其允许的受让人持有。
我们可要求赎回认股权证(不包括私人认股权证及为支付向我们提供的营运资金贷款而向内幕人士或其附属公司发出的任何额外认股权证),全部而非部分赎回,价格为每份认股权证0.01美元:
| ● | 在认股权证可行使后的任何时间, |
| ● | 在向每名认股权证持有人发出不少于30天的赎回书面通知后, |
250
| ● | 当且仅当所报告的普通股股份的最后出售价格等于或超过每股18.00美元(根据股票分割、股票股息、重组和资本重组进行调整)时,在认股权证可行使后的任何时间开始的30个交易日内的任何20个交易日内,直至向认股权证持有人发出赎回通知前的第三个营业日结束;以及 |
| ● | 当且仅当有一份现行登记声明对该认股权证的普通股股份有效时。 |
除非认股权证在赎回通知书所指明的日期前行使,否则行使权利将被没收。在赎回日期当日及之后,认股权证的记录持有人将没有其他权利,除非在交出认股权证时收到该持有人认股权证的赎回价格。
我们的认股权证的赎回标准所定的价格,旨在为认股权证持有人提供较初始行使价的合理溢价,并在当时的股价与认股权证行使价之间提供足够的差价,以便当股价因我们的赎回要求而下跌时,赎回将不会导致股价跌破认股权证的行使价。
如果我们如上所述要求赎回认股权证,我们的管理层将有权要求所有希望行使认股权证的持有者在“无现金基础上”行使认股权证。在这种情况下,每个持有人将通过放弃认股权证来支付行使价,该认股权证的数量等于认股权证所依据的普通股数量的乘积(x)乘以认股权证的行使价与“公平市场价值”(定义见下文)之间的差额乘以(y)公平市场价值所得的商。为此目的,“公允市场价值”是指在向认股权证持有人发出赎回通知之日前第三个交易日结束的十个交易日内,普通股股票的平均最后一次出售价格。
认股权证将根据作为认股权证代理的大陆集团与我们之间的认股权证协议以注册形式发出。《认股权证协议》规定,认股权证的条款可在未经任何持有人同意的情况下予以修改,以消除任何模糊之处或纠正任何有缺陷的条款,但须经当时尚未行使的公开认股权证的多数持有人书面同意或投票同意,才能作出对登记持有人的利益产生不利影响的任何变更。
在行使认股权证时可发行的普通股的行使价格和数量可能会在某些情况下进行调整,包括在股票股息、特别股息或我们的资本重组、重组、合并或合并的情况下。然而,除下文所述外,认股权证将不会因发行普通股的价格低于其各自的行使价格而调整。
此外,如果(x)我们在完成首次业务合并时,以低于每股普通股9.20美元的发行价格或有效发行价格(发行价格或有效发行价格由我们的董事会真诚地决定,在向内幕人士或其附属公司发行任何此类股票时,不考虑他们在发行前持有的任何创始人股份),为筹集资本的目的而发行额外的普通股或股票挂钩证券,(y)该等发行的所得款项总额,占于我们的首次业务合并完成当日可用作我们的首次业务合并的资金的股本所得款项总额及其利息(扣除赎回)的60%以上,及(z)我们的A类普通股的市值低于每股9.20元,认股权证的行使价会调整(至最接近的百分数),以相等于(i)市值或(ii)我们增发普通股或股票挂钩证券的价格两者中较高者的115%。
认股权证可于到期日或之前在认股权证代理人的办事处交回认股权证时行使,并按指示填妥和签立认股权证证书背面的行使表格,同时以经核证或正式银行支票全额支付行使价,以支付所行使的认股权证数目。认股权证持有人在行使其认股权证并获得普通股之前,不享有普通股股东的权利或特权,也不享有任何投票权。在行使认股权证后发行普通股后,每一持有人将有权就股东将投票表决的所有事项对记录在案的每一股份拥有一票表决权。
认股权证持有人可选择对其认股权证的行使加以限制,以使选择认股权证持有人不能行使其认股权证,但在行使认股权证后,该认股权证持有人将实益拥有超过已发行普通股股份9.8%的股份。
251
认股权证行使后将不会发行零碎股份。如果在行使认股权证时,持有人有权获得某部分股份的权益,我们将在行使认股权证时,将向该认股权证持有人发行的普通股股份的最接近的整数四舍五入。
股息
到目前为止,我们还没有为我们的普通股支付任何现金股息,也不打算在企业合并完成之前支付现金股息。未来现金股息的支付将取决于我们的收入和收益(如果有的话)、资本要求和企业合并完成后的一般财务状况。企业合并后的任何股息的支付将由我们当时的董事会酌情决定。我们的董事会目前打算保留所有收益,如果有的话,用于我们的业务运营,因此,我们的董事会预计在可预见的将来不会宣布任何股息。
我们的转让代理和授权代理
Continental Stock Transfer & Trust Company,One 道富,30th Floor,New York,New York 10004,是普通股的转让代理和公开认股权证的代理。
252
评估权
公众股东不享有与DGCL下的企业合并有关的评估权。
家庭信息
除非ACIC收到相反的指示,如果ACIC认为股东是同一家庭的成员,ACIC可以将本委托书/招股说明书的一份副本发送给有两个或两个以上股东居住的任何家庭。这一过程被称为“持家”,它减少了每户家庭收到的重复信息的数量,并有助于减少ACIC的开支。然而,如果股东希望今年或未来几年在同一地址收到多套ACIC的披露文件,股东应遵循以下说明。同样,如果一个地址与另一个股东共享,而两个股东都希望只收到一套ACIC的披露文件,股东应遵循以下指示:
如果普通股是以股东的名义登记的,股东应联系ACIC的办公室,地址是:Apeiron Capital Investment Corp.,联邦街175号,875套房,Boston,Massachusetts 02110。如果银行、经纪人或其他代名人持有股票,股东应直接与银行、经纪人或其他代名人联系
转让代理人和登记员
ACIC证券的转让代理是Continental Stock Transfer & Trust Company。
提交建议书
行政协调会理事会不知道可提交特别会议审议的任何其他事项。
未来提案
若要考虑将任何建议纳入我们的代理声明和提交股东的代理表格,在我们的下一次年度股东大会上提交给股东,假设业务合并已经完成,则必须以书面形式提交,并符合《交易法》第14a-8条和我们的章程的要求。
合并后公司的拟议章程将在企业合并完成后生效,其中规定了通知程序,供股东提议由股东在会议上审议的业务(董事提名除外)。为了及时,股东的通知必须由秘书在合并后公司的办公室收到,时间不迟于上一年度年会周年纪念日的第90天营业结束时,也不早于上一年度年会周年纪念日的第120天营业结束时,但如上一年度没有举行年会,或年会日期比上一年度年会周年纪念日提前了30天以上,或推迟了30天以上,我们预计合并后的公司年会将在合并完成后举行,股东必须在不早于合并前第120天的营业时间结束前,以及不迟于合并前第90天的营业时间结束前,或在合并后首次公开宣布合并日期的第10天的营业时间结束前,及时收到股东的通知。提名和提议还必须满足合并后公司拟议章程中规定的其他要求。合并后的公司董事会主席可拒绝承认提出了任何不符合上述程序的股东提案。
253
法律事项
根据本委托书/招股说明书所提供的证券的有效性将由ACIC的律师Ellenoff Grossman & Schole LLP,New York,NY传递。
专家
本委托说明书/招股说明书(其中载有关于对GIO持续经营能力存在重大疑问的解释性段落,如财务报表附注3所述)所载GIO截至2022年12月31日和2021年12月31日以及截至2022年12月31日止两年期间的合并财务报表,是依据独立注册会计师事务所PLLC Victor Mokuolo的报告编制的,该会计师事务所作为审计和会计方面的专家获得授权。
本委托说明书/招股说明书所载的截至2022年12月31日和截至2021年12月31日止年度的ACIC财务报表,已由独立注册会计师事务所Marcum LLP审计,其报告载于本委托说明书/招股说明书的其他部分(其中载有一段解释性段落,内容涉及对ACIC持续经营能力的重大怀疑,如财务报表附注1所述),并依据该事务所作为审计和会计专家的权威所提供的报告列入。
在哪里可以找到更多信息
ACIC向SEC提交年度和季度报告以及其他报告和信息。您可以在SEC网站上获取ACIC上的信息,其中包含报告、代理声明和其他信息,网址为:http://www.sec.gov。
ACIC已在S-4表格上提交了一份登记声明,以便在SEC登记ACIC将发行的与《企业合并协议》所设想的交易有关的证券。本代理声明/招股说明书是该登记声明的一部分,构成ACIC的招股说明书,以及ACIC在特别会议上的代理声明。
本委托书/招股说明书或本委托书/招股说明书的任何附件所载的信息和陈述,在所有方面均参照作为本委托书/招股说明书附件或展品提交的有关合同或其他文件的任何副本加以限定。
本文件所载与ACIC有关的所有信息均由ACIC提供,与GIO有关的所有此类信息均由GIO提供。ACIC或GIO或其各自代表提供的信息不构成对任何其他方的任何表示、估计或预测
如果您想要本文件的其他副本,或者如果您对业务合并有任何疑问,请在2023年[·]之前通过[·]联系ACIC的代理律师[·]。
254
财务报表索引
APEIRON CAPITAL INVESTMENT CORP。
|
页数 |
|
F-2 |
||
财务报表: |
||
F-3 |
||
F-4 |
||
F-5 |
||
F-6 |
||
F-7至F-20 |
GIO世界健康有限公司
|
页数 |
||
F-21 |
|||
F-23 |
|||
F-24 |
|||
F-25 |
|||
F-26 |
|||
F-27 |
|||
F-1
独立注册会计师事务所报告
致股东和董事会
Apeiron Capital Investment Corp.
关于财务报表的意见
我们审计了随附的Apeiron Capital Investment Corp.(简称“公司”)截至2022年12月31日和2021年12月31日的资产负债表、截至2022年12月31日止年度和2021年1月1日(开始运营)至2021年12月31日期间的相关经营报表、股东赤字变化和现金流量以及相关附注(统称“财务报表”)。我们认为,财务报表按照美利坚合众国普遍接受的会计原则,在所有重大方面公允反映了公司截至2022年12月31日和2021年12月31日的财务状况以及截至2022年12月31日止年度和2021年1月1日(开始运营)至2021年12月31日期间的经营成果和现金流量。
解释性段落-持续经营
所附财务报表的编制假设本公司将持续经营。正如财务报表附注1更全面地描述的那样,公司的业务计划取决于业务合并的完成情况,截至2022年12月31日,公司的现金和营运资金不足以完成其计划的活动。这些情况使人们对公司的持续经营能力产生了很大的怀疑。附注1还介绍了管理层关于这些事项的计划。财务报表不包括这种不确定性的结果可能导致的任何调整。
意见基础
这些财务报表是公司管理层的责任。我们的责任是根据我们的审计对公司的财务报表发表意见。我们是一家在美国上市公司会计监督委员会(“PCAOB”)注册的公共会计师事务所,根据美国联邦证券法以及证券交易委员会和PCAOB的适用规则和条例,我们必须对公司保持独立。
我们按照PCAOB的标准进行了审计。这些准则要求我们计划和进行审计,以便对财务报表是否不存在由于错误或欺诈造成的重大错报有合理的把握。本公司没有被要求对其财务报告的内部控制进行审计,我们也没有受聘进行审计。作为审计的一部分,我们需要了解财务报告的内部控制,但目的不是对公司财务报告内部控制的有效性发表意见。因此,我们不表示这种意见。
我们的审计包括执行评估财务报表重大错报风险的程序,无论是由于错误还是欺诈,以及执行应对这些风险的程序。这些程序包括在测试的基础上审查关于财务报表中的数额和披露的证据。我们的审计工作还包括评价管理层采用的会计原则和作出的重大估计,以及评价财务报表的总体列报方式。我们相信,我们的审计为我们的意见提供了合理的基础。
/S/Marcum LLP
Marcum LLP
我们从2021年开始担任公司的审计师。
纽约州纽约
2023年5月10日
PCAOB ID # 688
F-2
APEIRON CAPITAL INVESTMENT CORP。
资产负债表
|
12月31日, |
|||||
|
2022 |
|
2021 |
|||
物业、厂房及设备 |
|
|||||
现金 |
$ |
1,094,384 |
$ |
751,572 |
||
预付费用 |
177,083 |
234,215 |
||||
流动资产总额 |
1,271,467 |
985,787 |
||||
预付费用 |
— |
177,083 |
||||
信托账户中持有的现金和有价证券 |
16,182,549 |
175,952,082 |
||||
总资产 |
$ |
17,454,016 |
$ |
177,114,952 |
||
|
|
|
|
|||
LIABILITIES,REDEEMABLE COMMON Stock and Stockholders’DEFICIT |
|
|
|
|
||
流动负债----应计费用 |
$ |
830,785 |
$ |
191,193 |
||
应付所得税 |
588,493 |
— |
||||
强制性可赎回普通股负债 |
716,610 |
— |
||||
流动负债合计 |
2,135,888 |
191,193 |
||||
认股权证负债 |
|
2,523,750 |
|
8,580,750 |
||
应付递延承销费 |
|
9,075,000 |
|
9,075,000 |
||
负债总额 |
|
13,734,638 |
|
17,846,943 |
||
|
|
|
|
|||
承诺和或有事项(注6) |
|
|
|
|
||
可能赎回的A类普通股;面值0.0001美元;授权100,000,000股;2022年12月31日和2021年12月31日,分别为1,502,203股和17,250,000股,每股赎回价值10.24美元和10.20美元 |
15,381,820 |
175,950,000 |
||||
|
|
|
|
|||
股东赤字 |
|
|
|
|
||
优先股,面值0.0001美元;核准的1000000股;未发行和未发行 |
|
— |
|
— |
||
B类普通股,面值0.0001美元;授权10,000,000股;已发行和流通股4,312,500股 |
|
431 |
|
431 |
||
额外实收资本 |
|
— |
|
— |
||
累计赤字 |
|
(11,662,873) |
|
(16,682,422) |
||
股东赤字总额 |
|
(11,662,442) |
|
(16,681,991) |
||
总负债、可赎回普通股和股东赤字 |
$ |
17,454,016 |
$ |
177,114,952 |
||
附注是财务报表的组成部分。
F-3
APEIRON CAPITAL INVESTMENT CORP。
业务报表
|
期间 |
|||||
|
从1月1日起, |
|||||
|
2021 |
|||||
|
(生效日期 |
|||||
年度 |
|
业务) |
||||
结束 |
|
到12月 |
||||
|
2022年12月31日 |
|
|
31, 2021 |
||
业务和组建费用 |
$ |
1,203,615 |
|
$ |
234,315 |
|
业务损失 |
(1,203,615) |
(234,315) |
||||
|
|
|||||
其他收入(支出): |
|
|||||
信托账户持有的有价证券所赚取的利息 |
2,318,006 |
2,082 |
||||
认股权证负债公允价值变动 |
6,057,000 |
1,087,250 |
||||
与首次公开发行有关的交易费用 |
— |
(368,544) |
||||
其他收入,净额 |
8,375,006 |
720,788 |
||||
|
|
|||||
计提所得税前的收入 |
7,171,391 |
486,473 |
||||
准备金 |
(588,493) |
— |
||||
净收入 |
$ |
6,582,898 |
$ |
486,473 |
||
|
|
|||||
加权平均A类流通股,基本 |
|
16,730,842 |
2,569,149 |
|||
A类普通股基本净收入 |
$ |
|
$ |
0.08 |
||
加权平均B类流通股,基本 |
|
4,312,500 |
3,833,777 |
|||
B类普通股基本净收入 |
$ |
0.31 |
$ |
0.08 |
||
加权平均A类流通股,稀释 |
16,730,842 |
2,569,149 |
||||
A类普通股每股摊薄净收益 |
$ |
0.31 |
$ |
0.07 |
||
加权平均B类流通股,稀释 |
4,312,500 |
4,312,500 |
||||
B类普通股的稀释净收益 |
$ |
0.31 |
$ |
0.07 |
||
附注是财务报表的组成部分。
F-4
APEIRON CAPITAL INVESTMENT CORP。
股东赤字变动表
截至2022年12月31日止年度及自2021年1月1日起止期间(业务开始)
截至2021年12月31日
A类 |
B类 |
附加 |
合计 |
||||||||||||||||
普通股 |
普通股 |
实收 |
累计 |
股东" |
|||||||||||||||
|
股票 |
|
金额 |
|
股票 |
|
金额 |
|
资本 |
|
赤字 |
|
赤字 |
||||||
余额– 2021年1月1日(开始运营) |
— |
$ |
— |
— |
$ |
— |
$ |
— |
$ |
— |
$ |
— |
|||||||
|
|
|
|
|
|
|
|
|
|
|
|
||||||||
向初始股东发行B类普通股 |
— |
— |
4,312,500 |
431 |
24,569 |
— |
25,000 |
||||||||||||
收到的收益超过8,200,000份私募认股权证的公允价值,扣除发行成本 |
— |
— |
— |
— |
3,362,000 |
— |
3,362,000 |
||||||||||||
|
|
|
|
|
|
|
|||||||||||||
A类普通股对赎回金额的增值 |
— |
— |
— |
— |
(3,386,569) |
(17,168,895) |
(20,555,464) |
||||||||||||
净收入 |
|
— |
|
— |
— |
— |
|
— |
|
486,473 |
|
486,473 |
|||||||
余额– 2021年12月31日 |
— |
— |
4,312,500 |
431 |
— |
(16,682,422) |
(16,681,991) |
||||||||||||
A类普通股对赎回金额的增值 |
— |
— |
— |
— |
— |
(1,563,349) |
(1,563,349) |
||||||||||||
|
|
|
|
|
|
|
|||||||||||||
净收入 |
|
— |
|
— |
— |
— |
|
— |
|
6,582,898 |
|
6,582,898 |
|||||||
余额– 2022年12月31日 |
|
— |
$ |
— |
4,312,500 |
$ |
431 |
$ |
— |
$ |
(11,662,873) |
$ |
(11,662,442) |
||||||
附注是财务报表的组成部分。
F-5
APEIRON CAPITAL INVESTMENT CORP。
现金流量表
2021年1月1日起的期间(业务开始)
截至2021年12月31日及截至2022年12月31日止年度
|
期间 |
|||||
从1月1日起, |
||||||
2021 |
||||||
(开始 |
||||||
年度 |
业务) |
|||||
结束 |
通过 |
|||||
12月31日, |
12月31日, |
|||||
|
2022 |
|
2021 |
|||
经营活动产生的现金流量: |
|
|
||||
净收入 |
$ |
6,582,898 |
$ |
486,473 |
||
为调节净收入与业务活动所用现金净额而作出的调整: |
|
|
|
|
||
信托账户持有的有价证券所赚取的利息 |
(2,318,006) |
(2,082) |
||||
认股权证负债公允价值变动 |
(6,057,000) |
(1,087,250) |
||||
与首次公开发行有关的交易费用 |
— |
368,544 |
||||
经营资产和负债的变化: |
|
|
|
|
||
预付费用 |
234,215 |
(411,298) |
||||
应计费用 |
|
639,592 |
|
191,193 |
||
应付所得税 |
588,493 |
— |
||||
经营活动所用现金净额 |
|
(329,808) |
|
(454,420) |
||
投资活动产生的现金流量: |
||||||
信托账户现金投资 |
— |
(175,950,000) |
||||
从信托账户提取的现金用于支付特许经营税和所得税 |
672,620 |
— |
||||
从信托账户提取的与赎回有关的现金 |
161,414,919 |
— |
||||
投资活动提供(用于)的现金净额 |
162,087,539 |
(175,950,000) |
||||
|
|
|
|
|||
筹资活动产生的现金流量: |
|
|
|
|
||
向保荐人发行B类普通股所得款项 |
|
— |
|
25,000 |
||
出售单位的收益,扣除已支付的承销折扣 |
— |
169,500,000 |
||||
出售私募认股权证的收益 |
— |
8,200,000 |
||||
与本票有关的一方的收益 |
|
— |
|
226,638 |
||
与本票有关的一方的偿还 |
|
— |
|
(226,638) |
||
提供费用的支付 |
|
— |
|
(569,008) |
||
赎回普通股 |
(161,414,919) |
— |
||||
筹资活动提供的(用于)现金净额 |
|
(161,414,919) |
|
177,155,992 |
||
|
|
|
|
|||
现金净变动 |
|
342,812 |
|
751,572 |
||
现金–期初 |
|
751,572 |
|
— |
||
现金–期末 |
$ |
1,094,384 |
$ |
751,572 |
||
|
|
|
|
|
||
非现金投资和筹资活动: |
||||||
赎回价值的增值 |
$ |
1,563,349 |
$ |
20,555,464 |
||
应付递延承销费 |
$ |
— |
$ |
9,075,000 |
||
附注是财务报表的组成部分。
F-6
注1。组织、业务运营和流动性描述
Apeiron Capital Investment Corp.(简称“公司”)是一家于2020年12月28日在特拉华州注册成立的空白支票公司。公司成立的目的是与一个或多个企业进行合并、股本交换、资产收购、股票购买、重组或其他类似的业务合并(“业务合并”)。
本公司并不局限于某一特定行业或部门,以完成业务合并。本公司是一家处于早期阶段的新兴成长型公司,因此,本公司面临与处于早期阶段和新兴成长型公司相关的所有风险。
截至2022年12月31日的所有活动都与公司的组建、首次公开发行(“首次公开发行”)(如下所述)以及确定企业合并的目标公司有关。公司最早要等到业务合并完成后才能产生任何营业收入。公司从信托账户(定义见下文)持有的有价证券中以利息收入的形式产生营业外收入。
公司首次公开发行的注册声明已于2021年11月8日宣布生效。2021年11月12日,公司完成了17,250,000个单位的首次公开发行(“单位”,就所售单位中包含的A类普通股而言,“公众股份”),其中包括承销商以每单位10.00美元的价格全额行使其2,250,000个单位的超额配股权,产生的总收益为172,500,000美元,详见附注3。
在首次公开发行结束的同时,公司完成了以每份私募认股权证1.00美元的价格向Apeiron Capital Sponsor,LLC(“Sponsor”)和Cantor Fitzgerald & Co.(“Cantor”)出售8,200,000份认股权证(每份为“私募认股权证”,统称为“私募认股权证”),产生的总收益为8,200,000美元,见附注4。
交易费用为12644008美元,包括3000000美元的承销费、9075000美元的递延承销费和569008美元的其他发行费用。
在2021年11月12日首次公开发行结束后,出售首次公开发行的单位和出售私募认股权证的净收益中的175,950,000美元(每单位10.20美元)被存入一个信托账户(“信托账户”),并投资于《投资公司法》第2(a)(16)节规定的美国政府证券,期限为185天或更短,或在任何自称为货币市场基金的开放式投资公司,符合经修订的1940年《投资公司法》(《投资公司法》)第2a-7条规定的条件,由公司决定,直至以下两者中较早者:(一)完成业务合并或(二)将信托账户中的资金分配给公司股东,如下所述。
公司管理层在首次公开发行和出售私募认股权证的净收益的具体应用方面拥有广泛的酌处权,尽管基本上所有净收益都打算用于完成业务合并。不能保证公司能够成功地完成业务合并。公司必须完成一项或多项初始业务合并,其中一项或多项经营业务或资产的公允市场价值至少相当于信托账户(定义见下文)所持净资产的80%(减去任何递延承销佣金和信托账户所赚取的利息应缴纳的税款)。只有在企业合并后的公司拥有或收购目标公司50%或以上的已发行有表决权证券,或以其他方式获得目标公司的控股权益,足以使其不必根据《投资公司法》注册为投资公司时,公司才能完成企业合并。
本公司将向其已发行公众股份的持有人(“公众股东”)提供机会,在企业合并完成后(i)与为批准企业合并而召开的股东大会有关,或(ii)以要约收购的方式赎回其全部或部分公众股份。公司是否会寻求股东批准企业合并或进行要约收购,将由公司自行决定。公众股东将有权按信托账户当时金额的比例赎回其公众股份(最初为每股公众股份10.20美元,加上信托账户中持有但以前未发放的资金所赚取的任何按比例利息)
F-7
向公司支付其纳税义务)。公司的认股权证在业务合并完成后将不享有赎回权。
只有在企业合并完成之前或完成时,公司拥有至少5000,001美元的有形资产净值,并且如果公司寻求股东批准,投票的多数股份投票赞成企业合并,公司才会进行企业合并。如果法律不要求股东投票,而公司出于业务或其他原因不决定举行股东投票,公司将根据其经修订和重述的公司注册证书(“经修订和重述的公司注册证书”),根据美国证券交易委员会(“SEC”)的要约收购规则进行赎回,并在完成业务合并之前向SEC提交要约收购文件。但是,如果法律要求股东批准交易,或公司出于业务或其他原因决定获得股东批准,公司将根据代理规则而不是根据要约收购规则提出赎回股份,同时进行代理招标。如果公司就企业合并寻求股东批准,保荐人已同意将其创始人股份(定义见附注5)以及在首次公开发行期间或之后购买的任何公众股份投票赞成批准企业合并。此外,每个公众股东都可以选择赎回他们的公众股份,无论他们是支持还是反对拟议的交易,或者根本不投票。
尽管如此,如果公司寻求股东批准企业合并,但不按照要约收购规则进行赎回,经修订和重述的公司注册证书规定,公众股东,连同该股东的任何关联公司或与该股东一致行动的任何其他人,或作为“集团”(定义见经修订的1934年《证券交易法》(《交易法》)第13条),将被限制赎回其合计超过15%或以上的公众股份,未经公司事先同意。
保荐人已同意(a)放弃其就完成业务合并而持有的创始人股份及公众股份的赎回权,(b)如公司未能在首次公开发售结束后15个月内完成业务合并,则放弃其有关方正股份的清算权;及(c)不建议修订经修订及重订的法团证明书(i)以更改公司就公司的首次业务合并而有义务作出赎回或赎回其100%公众股份的实质或时间安排如公司并无完成任何业务合并,或(ii)就任何其他有关股东权利或首次业务合并前活动的条文,则除非公司为公众股东提供机会,在作出任何该等修订时赎回其公众股份。
从首次公开发行结束起,公司最初有15个月的时间完成业务合并,直至2023年2月12日。2022年12月21日,公司召开了一次特别会议,以代替召开2022年度股东大会。在会议上,公司股东批准了对公司经修订和重述的公司注册证书的修订,将公司完成首次业务合并的日期从2023年2月12日延长至2023年8月14日(“合并期”)。在这次会议上,持有公司A类普通股15,747,797股的股东行使了按比例赎回信托账户资金的权利。赎回后,公司有1,502,203股已发行公众股份。这导致信托账户支付了162131530美元,其中716610美元在2023年支付。如果公司无法在合并期内完成业务合并,公司将(i)停止所有业务,但清盘的目的除外;(ii)在合理可能的情况下,在不超过十个营业日的情况下,尽快赎回公众股份,每股价格以现金支付,相当于当时存入信托账户的总金额,包括从信托账户持有的资金中赚取的利息,而这些资金之前并未发放给公司以支付其纳税义务(减去支付解散费用的利息,最多不超过100,000美元),除以当时已发行的公众股份的数量,赎回将彻底取消公众股东作为股东的权利(包括获得进一步清算分配的权利,如果有),以及(iii)在赎回之后,在得到公司其余股东和公司董事会批准的情况下,在合理可能的范围内尽快解散和清算,但在每一种情况下,公司都有义务根据特拉华州法律规定债权人的债权和其他适用法律的要求。如果公司未能在合并期内完成业务合并,公司的认股权证将没有赎回权或清算分配,这些认股权证将一文不值。
如果公司未能在合并期内完成业务合并,保荐人已同意放弃其对创始人股份的清算权。但是,如果保荐人在首次公开发行期间或之后取得公开发行的股份
F-8
如果公司未能在合并期内完成业务合并,该等公众股份将有权从信托账户获得清算分配。承销商已同意,如果公司未能在合并期内完成业务合并,他们将放弃对其在信托账户中持有的递延承销佣金(见附注6)的权利,在这种情况下,这些金额将包括在信托账户中可用于赎回公众股份的其他资金中。在这种分配的情况下,剩余可供分配资产的每股价值可能低于每股公共股份10.20美元。
为保护信托账户中的金额,保荐人同意在第三方就向本公司提供的服务或销售的产品或本公司已讨论与之订立交易协议的潜在目标企业提出索赔时,对本公司承担责任,将信托账户中的资金数额减至以下两者中的较低数额:(1)每股公股10.20美元,或(2)截至信托账户清算之日信托账户中持有的每股公股实际数额,如果由于信托资产价值减少,减去应缴税款后,低于每股公股10.20美元,但这种赔偿责任不适用于第三方或潜在目标企业对信托账户所持资金的任何和所有权利作出放弃的任何索赔,也不适用于本公司对首次公开发行承销商的某些赔偿,包括根据经修订的1933年《证券法》(《证券法》)规定的赔偿责任而提出的任何索赔。此外,如果已执行的放弃被认为对第三方不可执行,担保人将不对此类第三方索赔承担任何赔偿责任。本公司将努力促使所有供应商、服务供应商(本公司的独立注册会计师事务所除外)、潜在目标企业或与本公司有业务往来的其他实体与本公司签订协议,放弃对信托账户所持款项或对信托账户所持款项的任何权利、所有权、权益或任何种类的债权,从而减少保荐人因债权人的债权而对信托账户进行赔偿的可能性。
流动性和持续经营
截至2022年12月31日,公司的经营银行账户中有1094384美元,信托账户中有16182549美元现金,用于进行企业合并或回购或赎回与此相关的普通股,营运资金赤字为63692美元,其中不包括特许经营税和所得税,因为这些款项可以从信托账户赚取的利息中支付。截至2022年12月31日,信托账户中约有1647468美元为利息收入,可用于支付公司的纳税义务。在截至2022年12月31日的年度内,公司从信托账户中提取了672620美元用于支付特许经营税和所得税,并提取了161414919美元用于支付赎回款项。
在完成业务合并之前,公司将利用信托账户中没有的资金来确定和评价可能的收购候选人,对可能的目标企业进行尽职调查,支付差旅费,选择要收购的目标企业,以及组织、谈判和完成业务合并。
公司可能需要通过从其发起人、股东、高级职员、董事或第三方的贷款或额外投资来筹集额外资金。公司的高级职员、董事和保荐人可以(但没有义务)随时或随时以他们认为合理的数额借出公司资金,以满足公司的营运资金需求。因此,公司可能无法获得额外的融资。如果公司无法筹集额外资金,可能需要采取额外措施以节省流动性,这些措施可能包括但不一定限于缩减业务、暂停进行潜在交易和减少管理费用。本公司不能保证,如果有的话,将以商业上可接受的条件向本公司提供新的融资。这些条件令人严重怀疑,如果企业合并未能完成,公司是否有能力在这些财务报表发布之日起的一年内持续经营。这些财务报表不包括在公司不能继续作为经营中企业时可能需要的与收回记录资产或负债分类有关的任何调整。
关于公司根据财务会计准则理事会(FASB)会计准则更新(ASU)2014-15年度主题“关于实体持续经营Ability的不确定性的披露”对持续经营考虑因素的评估,公司必须在2023年8月14日之前完成业务合并。目前尚不确定公司能否在此时完成业务合并。如果企业合并未能在此日期前完成,公司将被强制清算并随后解散。管理层已确定,如果不发生业务合并,流动性条件和强制性清算以及随后可能的
F-9
公司的解散使人对公司的持续经营能力产生了很大的怀疑。如果公司被要求在2023年8月14日之后清算,则未对资产或负债的账面金额进行调整。
风险和不确定性
管理层继续评估新冠疫情的影响,并得出结论认为,虽然该病毒有可能对公司的财务状况、经营业绩和/或寻找目标公司产生负面影响,但截至这些财务报表发布之日,具体影响尚无法确定。财务报表不包括这种不确定性的结果可能导致的任何调整。
2022年降低通胀法
2022年8月16日,《2022年降低通胀法》(简称“IR法”)签署成为联邦法律。除其他事项外,《投资者关系法》规定,2023年1月1日或之后,公开交易的美国国内公司和公开交易的外国公司的某些美国国内子公司对某些股票的回购将征收1%的新的美国联邦消费税。消费税是对回购公司本身征收的,而不是对回购股份的股东征收的。消费税的金额一般为回购时回购股份的公允市场价值的1%。不过,为计算消费税,回购法团可将某些新股发行的公平市值,与同一课税年度内股票回购的公平市值相抵。此外,某些例外适用于消费税。美国财政部(简称“财政部”)被授权提供法规和其他指导,以实施和防止滥用或逃避消费税。
在2022年12月31日之后发生的与企业合并、延期投票或其他有关的任何赎回或其他回购,可能需要缴纳消费税。公司会否就业务合并、延期表决或其他事项而须缴付消费税,以及在多大程度上须缴付消费税,将取决于多项因素,包括(i)与业务合并、延期或其他事项有关的赎回及回购的公平市值,(ii)业务合并的架构,(iii)与业务合并有关的任何“PIPE”或其他股本发行(或以其他方式并非与业务合并有关但在业务合并的同一课税年度内发行)的性质及款额,及(iv)库务署的规例及其他指引的内容。此外,由于消费税将由公司而非赎回持有人缴付,故尚未厘定任何所需缴付消费税的机制。上述情况可能导致完成业务合并的现有现金减少,并降低公司完成业务合并的能力。
注2。重要会计政策摘要
列报依据
所附财务报表的列报符合美利坚合众国普遍接受的会计原则(“GAAP”),并符合证券交易委员会的规则和条例。
新兴增长公司
该公司是一家“新兴成长型公司”。根据《证券法》第2(a)节的定义,经2012年《创业启动法》(“JOBS法”)修订,它可以利用适用于非新兴成长型公司的其他上市公司的各种报告要求的某些豁免,包括但不限于不被要求遵守《萨班斯-奥克斯利法》第404节的独立注册会计师事务所认证要求,在定期报告和代理声明中减少有关高管薪酬的披露义务,以及豁免就高管薪酬举行不具约束力的咨询投票和股东批准任何先前未获批准的金降落伞付款的要求。
此外,《JOBS法》第102(b)(1)条规定,新兴成长型公司无需遵守新的或经修订的财务会计准则,直至私营公司(即那些没有宣布生效的《证券法》登记声明或没有根据《交易法》登记的证券类别的公司)必须遵守新的或经修订的财务会计准则。JOBS法案规定,公司可以选择退出延长的过渡期
F-10
并遵守适用于非新兴成长型公司的要求,但任何选择退出的选择都是不可撤销的。本公司已选择不选择退出这一延长的过渡期,这意味着当一项准则被发布或修订,而其对上市公司或私营公司的适用日期不同时,本公司作为一家新兴成长型公司,可以在私营公司采用新的或修订的准则时采用新的或修订的准则。这可能会使公司的财务报表与另一家既不是新兴成长型公司也不是选择不使用延长过渡期的新兴成长型公司的上市公司进行比较变得困难或不可能,因为所使用的会计准则可能存在差异。
估计数的使用
按照公认会计原则编制财务报表,要求公司管理层作出估计和假设,这些估计和假设会影响资产和负债的报告数额,以及在财务报表日期披露或有资产和负债以及报告期间所报告的支出数额。
作出估计需要管理层作出重大判断。管理层在拟订其估计数时考虑到的在财务报表日期存在的条件、情况或一系列情况的影响的估计数,至少有合理的可能在近期内因一项或多项未来确定事件而发生变化。这些财务报表中包括的一个较重要的会计估计数是认股权证负债的公允价值的确定。随着可获得更多的最新信息,这种估计数可能会发生变化,因此,实际结果可能与这些估计数有很大差异。
现金及现金等价物
本公司将购买时原始期限为三个月或更短的所有短期投资视为现金等价物。截至2022年12月31日和2021年12月31日,公司没有任何现金等价物。
信托账户持有的有价证券
截至2022年12月31日,信托账户中持有的几乎所有资产均为现金。公司在信托账户中持有的所有投资都被归类为交易证券。交易证券在每个报告期末按公允价值在资产负债表上列报。信托账户所持投资的公允价值变动产生的收益和损失在随附的业务报表中列入信托账户所持有价证券的利息。信托账户所持投资的估计公允价值是根据现有的市场信息确定的。
可予赎回的A类普通股
公司根据会计准则编纂(ASC)主题480“区分负债与权益”中的指导原则,对可能赎回的A类普通股进行会计处理。被强制赎回的A类普通股被归类为一种负债工具,并以公允价值计量。有条件可赎回的A类普通股(包括具有赎回权的A类普通股,其赎回权在持有人的控制范围内,或在发生不确定事件时可赎回,而不是仅在公司的控制范围内)被归类为临时股权。在其他任何时候,A类普通股都被归为股东权益。公司的A类普通股具有某些赎回权,这些赎回权被认为不在公司的控制范围内,可能会发生不确定的未来事件。因此,在2022年12月31日和2021年12月31日,可能赎回的A类普通股在公司资产负债表的股东赤字部分之外,以赎回价值作为临时权益列报。
本公司在赎回价值发生变化时立即予以确认,并在每个报告期末将可赎回A类普通股的账面价值调整为与赎回价值相等。可赎回A类普通股的账面金额的增减受额外实收资本(在可动用的范围内)和累计亏损的影响。
F-11
在2022年12月31日和2021年12月31日,资产负债表中反映的A类普通股在下表中进行了调节:
总收益 |
|
$ |
172,500,000 |
减: |
|
|
|
分配给公开认股权证的收益 |
(4,830,000) |
||
A类普通股发行费用 |
(12,275,464) |
||
加: |
|
|
|
账面价值对赎回价值的增值 |
20,555,464 |
||
可赎回的A类普通股,2021年12月31日 |
175,950,000 |
||
减: |
|||
赎回 |
(161,414,919) |
||
强制性可赎回普通股负债 |
(716,610) |
||
加: |
|||
账面价值对赎回价值的增值 |
1,563,349 |
||
可赎回的A类普通股,2022年12月31日 |
$ |
15,381,820 |
所得税
该公司根据ASC主题740“所得税”核算所得税。ASC主题740,所得税,要求确认递延所得税资产和负债,既考虑到财务报表和资产和负债计税基础之间差异的预期影响,也考虑到税收损失和税收抵免结转产生的预期未来税收优惠。ASC专题740还要求,如果递延所得税资产的全部或部分很可能无法变现,则应确定估值备抵。截至2022年12月31日和2021年12月31日,公司的递延所得税资产有全额估值备抵。
ASC主题740还澄清了企业财务报表中确认的所得税不确定性的会计处理,并规定了财务报表确认的确认门槛和计量过程,以及对纳税申报表中已采取或预期将采取的税务状况的计量。要使这些好处得到承认,在税务当局审查后,税务状况必须更有可能维持下去。ASC主题740还提供了关于终止确认、分类、利息和罚款、中期会计、披露和过渡的指导。
公司将与未确认的税收优惠相关的应计利息和罚款确认为所得税费用。截至2022年12月30日和2021年12月30日,不存在未确认的税收优惠,也不存在应计利息和罚款金额。公司目前不知道有任何正在审查的问题可能导致大量付款、应计费用或严重偏离其地位。
该公司已将美国确定为其唯一的主要税务管辖区。本公司自成立以来一直由主要税务机关征收所得税。这些检查可能包括质疑扣减的时间和数额、不同税收管辖区之间的收入关系以及遵守联邦和州税法的情况。公司管理层预计,未来12个月内,未确认的税收优惠总额不会发生重大变化。
普通股每股净收益
公司遵守ASC主题260“每股收益”的会计和披露要求。普通股每股净收益的计算方法是将净收益除以该期间已发行普通股的加权平均数。与A类普通股可赎回股份相关的增值不计入每股收益,因为赎回价值接近公允价值。
每股摊薄收益的计算并未考虑与(i)首次公开发行和(ii)私募有关的认股权证的影响,因为认股权证的行使取决于未来事件的发生。认股权证可用于购买总计16,825,000股A类普通股。截至2022年12月31日和2021年12月31日,公司没有任何稀释性证券或其他可能被行使或转换为普通股然后分享公司收益的合同。
F-12
下表反映了每股普通股基本和摊薄净亏损的计算(以美元计,每股金额除外):
从 |
||||||||||||
2021年1月1日 |
||||||||||||
(开始 |
||||||||||||
截至本年度 |
操作)通过 |
|||||||||||
2022年12月31日 |
2021年12月31日 |
|||||||||||
|
A类 |
|
B类 |
|
A类 |
|
B类 |
|||||
每股普通股基本净收入 |
|
|
||||||||||
分子: |
|
|
||||||||||
经调整的净收入分配 |
$ |
5,233,837 |
$ |
1,349,061 |
$ |
195,195 |
$ |
291,278 |
||||
分母: |
|
|
||||||||||
基本加权平均流通股 |
16,730,842 |
4,312,500 |
|
2,569,149 |
|
3,833,777 |
||||||
每股普通股基本净收入 |
$ |
0.31 |
$ |
0.31 |
$ |
0.08 |
$ |
0.08 |
||||
每股普通股摊薄净收益 |
|
|
|
|
||||||||
分子: |
|
|
|
|
||||||||
经调整的净收入分配 |
$ |
5,233,837 |
$ |
1,349,061 |
$ |
181,617 |
$ |
304,856 |
||||
分母: |
|
|
|
|
||||||||
稀释加权平均流通股 |
16,730,842 |
4,312,500 |
|
2,569,149 |
|
4,312,500 |
||||||
每股普通股摊薄净收益 |
$ |
0.31 |
$ |
0.31 |
$ |
0.07 |
$ |
0.07 |
||||
信贷风险集中
可能使公司面临集中信贷风险的金融工具包括金融机构的现金账户,这些账户有时可能超过联邦存款保险公司250000美元的承保限额。公司在这些账目上没有出现亏损。
衍生金融工具
本公司对其金融工具进行评估,以确定这些工具是衍生品还是包含符合ASC主题815“衍生品和套期保值”规定的嵌入衍生品的特征。衍生工具最初按公允价值入账,并在每个报告日重新估值,公允价值变动在业务报表中报告。衍生资产和负债在资产负债表中根据是否需要在资产负债表日起12个月内以现金净额结算或转换工具,分为流动资产和非流动资产。
发行成本
公司遵守ASC 340-10-S99-1和SEC员工会计公告主题5A ——“发行费用”的要求。发行费用包括承销、法律、会计和其他因首次公开发行而产生的与首次公开发行直接相关的费用。发行成本按相对公允价值与所得收益总额相比较,分配给在首次公开发行中发行的可分离金融工具。与衍生权证负债相关的发行成本在发生时计入费用,并作为营业外支出列报。发行费用为12644008美元,其中12275464美元记入首次公开发行完成后的股东赤字,368544美元记入业务费用。
金融工具的公允价值
根据ASC主题820“公允价值计量”,本公司资产和负债的公允价值接近于所附资产负债表中的账面金额,主要是由于其短期性质,但权证负债除外(见附注10)。
F-13
公允价值计量
公允价值的定义是,在计量日市场参与者之间的有序交易中,出售资产所收到的价格或转移负债所支付的价格。公认会计原则建立了一个三层公允价值层次结构,它优先考虑用于计量公允价值的输入。等级制度给予相同资产或负债活跃市场中未经调整的报价最高优先(第1级计量),给予不可观测投入最低优先(第3级计量)。这些层级包括:
| ● | 第1级,定义为可观察的投入,如活跃市场中相同工具的报价(未经调整); |
| ● | 第2级,定义为除活跃市场的报价外,可直接或间接观察到的投入,例如活跃市场中类似工具的报价或不活跃市场中相同或类似工具的报价;以及 |
| ● | 第3级,定义为存在很少或根本没有市场数据的不可观察的投入,因此要求一个实体制定自己的假设,例如根据一项或多项重要投入或重要价值驱动因素不可观察的估值技术得出的估值。 |
在某些情况下,用于计量公允价值的投入可能被归入公允价值层次结构的不同层次。在这些情况下,公允价值计量在公允价值层次结构中根据对公允价值计量具有重要意义的最低层次输入值进行整体分类。
认股权证负债
本公司根据ASC主题815“衍生工具和套期保值”中所载的指导意见,对与首次公开发行和私募发行有关的认股权证进行会计处理,根据该规定,认股权证不符合股权处理标准,必须记为负债。因此,本公司将认股权证归类为按公允价值计算的负债,并在每个报告期将认股权证调整为按公允价值计算的负债。该负债将在每个资产负债表日重新计量,直至认股权证被行使或到期,公允价值的任何变动将在公司的经营报表中确认。
最近的会计准则
管理层认为,任何最近颁布但尚未生效的会计准则,如果目前得到采用,都不会对公司的财务报表产生重大影响。
注3。首次公开发行
根据首次公开发行,该公司出售了17,250,000个单位,其中包括承销商充分行使其超额分配选择权,数额为2,250,000个单位,购买价格为每单位10.00美元。每个单位包括一股公司的A类普通股和一份可赎回认股权证(“公开认股权证”)的二分之一。每份公开认股权证赋予持有人以每股11.50美元的行使价格购买一股A类普通股的权利(见附注8)。
注4。定向增发
在首次公开发行结束的同时,保荐人和Cantor、承销商代表以每份私募认股权证1.00美元的价格购买了总计8200000份私募认股权证,总购买价为8200000美元。每份私募认股权证可按每股11.50美元的价格购买一股A类普通股,但可作调整(见附注8)。私募权证收益的一部分被添加到信托账户中持有的首次公开发行收益中。如果公司没有在合并期内完成业务合并,出售私募认股权证的收益将用于赎回公众股份(但须符合适用法律的规定),而私募认股权证将一文不值。
F-14
注5。关联方交易
方正股份
2021年2月5日,保荐人购买了公司B类普通股的5,750,000股(“创始人股份”),总价为25,000美元。于2021年8月4日,保荐人免费向公司退还注销的合计1,437,500股方正股份,从而使保荐人持有的合计4,312,500股方正股份流通在外。Founder的股份包括总计高达562,500股的股份,如果承销商的超额配股权未全部行使,保荐人将予以没收。由于承销商全额行使了超额配股权,因此没有创始人的股份可以被没收。
除某些有限的例外情况外,保荐人同意不转让、转让或出售任何创始人股份,直至以下较早的情况发生:(1)在企业合并完成后一年后或(B)在企业合并之后,(x)在企业合并之后至少180天开始的30个交易日内的任何20个交易日内,A类普通股最后报告的出售价格等于或超过每股12.00美元(根据股票分割、股息、重组、资本重组等调整),或(y)公司完成清算、合并、股本交换或其他类似交易的日期,而该等交易导致公司所有股东有权将其普通股股份换成现金、证券或其他财产。
行政服务协议
公司签订了一项协议,自2021年11月8日起至公司完成业务合并和清算的较早日期,每月向保荐人支付总计10000美元的办公空间、水电费以及秘书和行政支助费用。在截至2022年12月31日的年度和2021年1月1日(开始运营)至2021年12月31日期间,公司为这些服务支付了120,000美元和20,000美元的费用,这些费用包括在所附资产负债表的应计费用中。
本票—关联方
2021年2月5日,保荐人向公司发行了一张无担保本票(经修订的“本票”),据此,公司可借入本金总额不超过300,000美元的资金。本票不计息,应于2022年3月31日或首次公开发行完成时支付。在2021年11月12日首次公开发行结束时,已偿还本票项下的未偿余额226638美元。
关联方贷款
为了支付与企业合并有关的交易费用,保荐人或保荐人的关联公司或公司的某些董事和高级管理人员可以(但无义务)根据需要向公司提供贷款(“周转贷款”)。如果公司完成业务合并,公司将从发放给公司的信托账户的收益中偿还周转贷款。否则,只能用信托账户以外的资金偿还周转贷款。在企业合并未结束的情况下,公司可使用信托账户以外的部分收益偿还周转贷款,但信托账户中的收益将不用于偿还周转贷款。周转贷款要么在企业合并完成后偿还,不计利息,要么由贷款人酌情决定,最多可将1500000美元的周转贷款转换为企业合并后实体的权证,每份权证的价格为1.00美元。认股权证将与私募认股权证相同。截至2022年12月31日和2021年12月31日,没有未偿还的流动资金贷款。
注6。承诺与或有事项
登记权
根据2021年11月8日订立的登记权协议,创始人股份、私募认股权证及在周转贷款转换时可发行的认股权证(以及在行使私募认股权证时可发行的任何A类普通股股份及在
F-15
营运资金贷款和创始人股份转换后)有权获得登记权,要求公司登记这些证券以供转售(创始人股份的情况下,只有在转换为我们的A类普通股之后)。大部分证券的持有人将有权提出最多三项要求,要求公司登记这些证券,但不包括简短的登记要求。此外,对于在企业合并完成后提交的登记声明,持有人拥有某些“附带”登记权,并有权要求公司根据《证券法》第415条进行转售此类证券的登记。登记权协议不包含因公司证券登记延迟而产生的违约金或其他现金结算条款。本公司将承担因提交任何该等注册声明而招致的开支。
包销协议
承销商有权收取递延费用:(一)在首次公开发行中最初售出的15000000个单位,每单位0.50美元,或总额7500000美元;(二)根据超额分配选择权售出的单位0.70美元,或总额不超过1575000美元。递延费用将仅在公司完成业务合并时从信托账户中持有的金额中支付给承销商,但须遵守承销协议的条款。
注7。股东赤字
优先股——本公司获准发行1,000,000股面值0.0001美元的优先股。截至2022年12月31日和2021年12月31日,没有已发行或流通的优先股。
A类普通股——公司被授权发行最多100,000,000股A类普通股,面值0.0001美元。公司普通股股东每持有一股有权投一票。截至2022年12月31日和2021年12月31日,没有已发行或流通的A类普通股,不包括分别为1,502,203股和17,250,000股的临时股本可能赎回。
B类普通股——本公司被授权发行最多10,000,000股B类普通股,面值0.0001美元。公司普通股股东每持有一股有权投一票。截至2022年12月31日和2021年12月31日,已发行和流通的B类普通股共有4,312,500股。
A类普通股和B类普通股的持有者将作为一个单一类别,就提交给股东投票的所有其他事项共同投票,除非法律要求。
在企业合并时,B类普通股的股份将自动转换为A类普通股的股份,但可能会有所调整。如A类普通股或与股票挂钩的证券的额外股份的发行或当作发行的数额超过首次公开发行的数额,并与企业合并的结束有关,B类普通股转换为A类普通股的比率将予调整(除非持有本公司B类普通股已发行及未发行股份的多数股东同意豁免就任何该等发行或当作发行作出的反稀释调整),以使B类普通股的所有股份转换后可发行的A类普通股的股份总数,在转换后的基础上,首次公开发行完成时已发行和未发行的所有普通股股份的20%,加上我们就企业合并而发行或被视为发行的所有A类普通股和股票挂钩证券的股份(不包括在企业合并中向任何卖方发行或将发行的任何股票或股票挂钩证券,以及在向公司提供的贷款转换后向保荐人或其关联公司发行的任何私募等价认股权证)。
注8。认股权证
截至2022年12月31日和2021年12月31日,共有8,625,000份公开认股权证已发行和未到期。公开认股权证只可对全部股份行使。在行使公开认股权证时,不会发行零碎股份。公开认股权证将于以下日期中较晚的日期行使:(a)企业合并完成后30天,或(b)首次公开发行结束后12个月。公开认股权证自企业合并完成之日起五年或在赎回或清算时更早到期。
F-16
公司没有义务根据公开认股权证的行使交付任何A类普通股,也没有义务结算这种公开认股权证的行使,除非根据《证券法》发布的关于在公开认股权证行使时可发行的A类普通股的登记声明当时生效,并且相关的招股说明书是现行的,前提是公司履行其有关登记的义务。任何认股权证均不可行使,公司亦无义务在认股权证行使时发行A类普通股,除非认股权证行使时可发行的A类普通股已根据认股权证登记持有人的居住国证券法进行登记、符合资格或被视为豁免。
公司已同意,在切实可行的情况下,但在不迟于企业合并完成后15个工作日的情况下,公司将尽最大努力向美国证券交易委员会提交一份登记声明,涵盖在行使认股权证时可发行的A类普通股的股份,以使该登记声明生效,并维持与这些A类普通股股份有关的当前招股说明书,直至认股权证协议规定的认股权证到期或赎回为止。如果在企业合并结束后第60个营业日之前,涵盖在行使认股权证时可发行的A类普通股股份的登记声明不能生效,认股权证持有人可以根据《证券法》第3(a)(9)节或其他豁免,以“无现金方式”行使认股权证,直至有有效的登记声明为止,并在公司未能保留有效登记声明的任何期间内。尽管有上述规定,如果一份涵盖在行使认股权证时可发行的A类普通股的登记声明在企业合并完成后的指定期间内无效,认股权证持有人可以根据经修订的1933年《证券法》或《证券法》第3(a)(9)节规定的豁免在无现金基础上行使认股权证,直至有一份有效的登记声明为止,并且在公司未能保留有效登记声明的任何期间内,只要这种豁免是可用的。如果不能获得这一豁免或另一项豁免,持有者将无法在无现金的基础上行使其认股权证。
一旦认股权证可予行使,本公司可在下列情况下赎回公开认股权证:
| ● | 全部而不是部分; |
| ● | 代价是$
|
| ● | 不少于 |
| ● | 当且仅当报告的A类普通股最后出售价格等于或超过$
|
如果认股权证可由公司赎回,如果在行使认股权证时发行普通股不能根据适用的州蓝天法律豁免登记或获得资格,或者公司不能进行此种登记或获得资格,则公司不得行使其赎回权。
如果公司要求赎回公开认股权证,管理层将有权要求所有希望行使公开认股权证的持有人按照认股权证协议的规定,在“无现金基础上”行使公开认股权证。在行使认股权证时可发行的A类普通股的行使价格和股票数量在某些情况下可能会有所调整,包括在股票分红、资本重组、重组、合并或合并的情况下。然而,除下文所述外,认股权证不会因A类普通股的发行价格低于其行使价而调整。此外,在任何情况下,本公司都不需要以现金净额结算认股权证。如果公司无法在合并期内完成业务合并,而公司将清算信托账户中的资金,权证持有人将不会收到与其权证相关的任何此类资金,也不会从信托账户以外的公司资产中获得与此类权证相关的任何分配。因此,认股权证可能到期时一文不值。
此外,如果(x)公司发行额外的A类普通股或与股票挂钩的证券,以筹集与企业合并结束有关的资本,发行价格或有效发行价格低于每股A类普通股9.20美元(发行价格或有效发行价格由公司董事会善意确定,如果是向保荐人或其附属公司发行,则不考虑保荐人或其附属公司所持有的任何创始人股份(如适用),在此种发行之前)(“新发行价格”),(y)从
F-17
此类发行占企业合并完成之日可用于为企业合并提供资金的总股本收益及其利息的60%以上(扣除赎回),以及(z)在公司完成企业合并之日后的交易日开始的20个交易日期间,公司A类普通股的成交量加权平均交易价格(该价格,即“市场价值”)低于每股9.20美元,认股权证的行使价将被调整(至最接近的百分数),以等于市值和新发行价格两者中较大者的115%,而每股18.00美元的赎回触发价将被调整(至最接近的百分数),以等于市值和新发行价格两者中较大者的180%。
截至2022年12月31日和2021年12月31日,已发行和未发行的私募认股权证为8,200,000份。私募认股权证与首次公开发行中出售的单位的公开认股权证相同,但私募认股权证和行使私募认股权证后可发行的普通股在企业合并完成后30天内不得转让、转让或出售,但有某些有限的例外情况。此外,私人配售认股权证将可在无现金基础上行使,且只要由初始购买者或其获准受让人持有,则不可赎回。如私人配售认股权证并非由首次购买人或其准许受让人持有,则私人配售认股权证将可由公司赎回,并可由该等持有人按与公开认股权证相同的基准行使。
注9。所得税
本公司于2022年12月31日和2021年12月31日的递延所得税资产净额如下:
|
12月31日, |
|||||
|
2022 |
|
2021 |
|||
递延所得税资产(负债) |
|
|
|
|
||
业务亏损结转净额 |
$ |
— |
$ |
6,360 |
||
开办/组织费用 |
|
346,878 |
|
42,409 |
||
递延所得税资产总额(负债) |
346,878 |
48,769 |
||||
估价津贴 |
|
(346,878) |
|
(48,769) |
||
递延所得税资产(负债) |
$ |
— |
$ |
— |
||
2022年12月31日终了年度和2021年1月1日(业务开始)至2021年12月31日期间的所得税准备金包括:
|
12月31日, |
|||||
|
2022 |
|
2021 |
|||
联邦 |
||||||
当前 |
$ |
452,356 |
$ |
|||
推迟 |
(217,865) |
(48,769) |
||||
国家 |
||||||
当前 |
$ |
136,137 |
$ |
— |
||
推迟 |
(80,244) |
— |
||||
估值备抵变动 |
298,109 |
48,769 |
||||
所得税拨备 |
$ |
588,493 |
$ |
— |
||
截至2022年12月31日和2021年12月31日,公司有0美元和30,284美元的美国联邦和州净营业亏损可用于抵消未来的应税收入。
在评估递延税项资产(负债)的变现情况时,管理层考虑的是,所有递延税项资产的某些部分是否更有可能无法变现。递延所得税资产的最终变现取决于代表未来可抵扣净额的暂时性差异可抵扣期间内未来应纳税所得额的产生。管理当局考虑递延税务负债的预定转回、预计未来应课税收入和税
F-18
在进行这一评估时规划战略。在审议了所有现有资料后,管理层认为,递延税款资产的未来变现存在很大的不确定性,因此设立了全额估值备抵。2022年12月31日终了年度和2021年1月1日(业务开始)至2021年12月31日期间,估值备抵的变动分别为298109美元和48769美元。
2022年12月31日和2021年12月31日联邦所得税税率与公司实际税率的对账如下:
|
12月31日, |
||||||
|
2022 |
|
2021 |
||||
法定联邦所得税率 |
21.0 |
% |
21.0 |
% |
|||
州税,扣除联邦税收优惠 |
6.3 |
% |
0.0 |
% |
|||
上一年真实 |
(0.2) |
% |
0.0 |
% |
|||
与首次公开发行有关的交易费用 |
0.0 |
% |
15.9 |
% |
|||
认股权证负债公允价值变动 |
(23.1) |
% |
(46.9) |
% |
|||
餐饮和娱乐 |
0.0 |
% |
0.0 |
% |
|||
估价津贴 |
4.2 |
% |
10.0 |
% |
|||
所得税拨备 |
8.2 |
% |
0.0 |
% |
|||
该公司在美国联邦管辖区和马萨诸塞州提交所得税申报表。公司截至2021年12月31日止年度的纳税申报表仍待审核。
注10。公允价值
下表列出了2022年12月31日、2022年12月31日和2021年12月31日以经常性公允价值计量的公司资产和负债的信息,并显示了公司用于确定此类公允价值的估值投入的公允价值等级:
|
|
12月31日, |
||||||
说明 |
|
水平 |
|
2022 |
|
2021 |
||
资产: |
|
|
|
|
|
|
||
信托账户持有的有价证券 |
|
1 |
$ |
16,182,549 |
$ |
175,952,082 |
||
负债: |
|
|
|
|
|
|
||
认股权证责任–公开认股权证 |
1 |
$ |
1,293,750 |
$ |
— |
|||
认股权证责任–公开认股权证 |
3 |
— |
$ |
4,398,750 |
||||
认股权证责任–私人配售认股权证 |
|
3 |
$ |
1,230,000 |
$ |
4,182,000 |
||
根据ASC 815-40的规定,认股权证作为负债入账,并在所附资产负债表的认股权证负债中列报。认股权证负债在初始和经常性基础上按公允价值计量,公允价值变动在业务报表中列报。
公司利用蒙特卡洛模拟模型在每个资产负债表日对公开认股权证和私募认股权证进行估值,并在业务报表中确认公允价值的变动。认股权证负债的估计公允价值使用第3级输入值确定。定价模型中固有的是与预期股价波动、预期寿命和无风险利率相关的假设。公司根据与认股权证预期剩余寿命相匹配的历史波动率估计其普通股的波动率。无风险利率基于授予日美国国债零息收益率曲线,期限与认股权证的预期剩余期限类似。认股权证的预期寿命假定与其剩余的合同期限相当。由于在活跃市场中使用了可观察到的市场报价,在公开担保从单位分离后,随后对公开担保的计量被归类为第1级。
F-19
下表提供了蒙特卡洛方法对公开认股权证和私募认股权证公允价值的重要投入:
公共和私人 |
|||||||
认股权证 |
私人认股权证 |
||||||
12月31日, |
12月31日, |
||||||
|
2021 |
|
2022 |
||||
股票价格 |
$ |
9.83 |
$ |
10.26 |
|||
行权价格 |
$ |
11.50 |
$ |
11.50 |
|||
股息收益率 |
— |
% |
|
— |
% |
||
预期任期(年) |
5.86 |
|
5.62 |
||||
波动性 |
8.7 |
% |
5.90 |
% |
|||
无风险利率 |
1.33 |
% |
|
3.90 |
% |
||
下表提供了关于第3级公允价值计量的定量信息:
|
公共 |
|
|
|
|||||
认股权证 |
私人认股权证 |
认股权证共计 |
|||||||
|
负债 |
|
负债 |
|
负债 |
||||
截至2021年1月1日的公允价值 |
|
|
|
|
$ |
|
|||
2021年11月12日初步测量 |
|
4,830,000 |
|
4,838,000 |
|
9,668,000 |
|||
公允价值变动 |
(431,250) |
(656,000) |
(1,087,250) |
||||||
截至2021年12月31日的公允价值 |
|
4,398,750 |
|
4,182,000 |
|
8,580,750 |
|||
转入第1级 |
(4,398,750) |
— |
(4,398,750) |
||||||
公允价值变动 |
— |
(2,952,000) |
(2,952,000) |
||||||
截至2022年12月31日的公允价值 |
$ |
— |
$ |
1,230,000 |
$ |
1,230,000 |
|||
转入/转出第1、2和3级的款项在估值技术或方法发生变化的报告期末确认。在2022年12月31日终了年度,公开担保从第3级计量转入第1级公允价值计量的估计公允价值为4398750美元,当时公开担保是单独上市和交易的。在2021年1月1日至2021年12月31日期间,没有发生从第3级转移的情况。
注11。后续事件
公司评估了在资产负债表日期之后直至财务报表发布之日发生的后续事件和交易。根据这一审查,除以下情况外,公司没有发现任何需要在财务报表中进行调整或披露的后续事件。
2023年1月31日,我们收到纽约证券交易所工作人员的书面通知,称我们没有遵守《纽约证券交易所上市公司手册》第802.01B节的规定,该节要求上市公司在连续30个交易日内保持其公开持有的股票的平均全球总市值至少为40,000,000美元。因此,这些公开发行的证券从纽约证券交易所退市。
F-20
独立注册会计师事务所报告
股东,
GIO世界健康有限公司
文洛克路22号
伦敦N1 7GU英格兰
关于财务报表的意见
我们审计了随附的GIO World Health Limited(本公司)截至2022年12月31日和2021年9月20日(成立)至2021年12月31日期间的资产负债表,以及截至2022年12月31日期间和年度的相关经营、股东权益和现金流量表,以及相关附注(统称为财务报表)。我们认为,财务报表按照美利坚合众国普遍接受的会计原则,在所有重大方面公允反映了公司截至2022年12月31日止年度和2021年9月20日(成立)至2021年12月31日止期间的财务状况,以及截至2022年12月31日止期间和年度的经营成果和现金流量。
对公司持续经营能力的严重怀疑
所附财务报表的编制假设本公司将持续经营。如财务报表附注3所述,公司在截至2022年12月31日的年度和截至2021年12月31日的期间出现经营亏损,在2022年12月31日出现累计亏损,公司并没有产生足以支付长期经营成本的收入。这些因素使人们对其持续经营的能力产生了很大的怀疑。说明3还介绍了管理部门关于这些事项的计划。财务报表不包括这种不确定性的结果可能导致的任何调整。
意见基础
这些财务报表是公司管理层的责任。我们的责任是根据我们的审计对公司的财务报表发表意见。我们是一家在美国上市公司会计监督委员会(PCAOB)注册的公共会计师事务所,根据美国联邦证券法以及美国证券交易委员会和PCAOB的适用规则和条例,我们必须对公司保持独立。
我们按照PCAOB的标准进行了审计。这些准则要求我们计划和进行审计,以便对财务报表是否不存在由于错误或欺诈造成的重大错报有合理的把握。本公司没有被要求对其财务报告的内部控制进行审计,我们也没有受聘进行审计。作为审计的一部分,我们需要了解财务报告的内部控制,但目的不是对公司财务报告内部控制的有效性发表意见。因此,我们不表示这种意见。
我们的审计包括执行评估财务报表重大错报风险的程序,无论是由于错误还是欺诈,以及执行应对这些风险的程序。这些程序包括在测试的基础上审查关于财务报表中的数额和披露的证据。我们的审计还包括评价管理层采用的会计原则和作出的重大估计,以及评价财务报表的总体列报方式。我们认为,我们的审计为我们的意见提供了合理的基础。

F-21
关键审计事项
关键审计事项是指本期对财务报表的审计所产生的事项,这些财务报表已传达或要求传达给审计委员会或公司治理,并且:(1)涉及对财务报表具有重要意义的账目或披露;(2)涉及我们特别具有挑战性、主观或复杂的判断。关键审计事项的通报不会以任何方式改变我们对整个财务报表的意见,我们也不会通过通报关键审计事项,就关键审计事项或与其有关的账目或披露事项单独提出意见。我们确定,没有向审计委员会通报或要求通报任何重大审计事项。
|
|
|
我们自2022年起担任公司的审计师。 |
||
德克萨斯州休斯顿 |
||
2023年5月10日 |
||
PCAOB编号:6771 |

F-22
GIO世界健康有限公司
资产负债表
截至2022年12月31日和2021年12月31日
|
英镑 |
|
英镑 |
|||
12/31/22 |
12/31/21 |
|||||
物业、厂房及设备 |
|
|
|
|
||
当前资产: |
|
|
|
|
||
TAG银行的现金 |
|
£ |
14,706 |
|
£ |
83,914 |
现金总额 |
|
14,706 |
|
83,914 |
||
流动资产总额 |
|
14,706 |
|
83,914 |
||
预付费用和存款 |
|
9,844 |
|
125,783 |
||
非流动资产: |
|
24,550 |
|
209,697 |
||
总资产 |
|
£ |
24,550 |
|
£ |
209,697 |
负债和股东权益 |
|
|
|
|
||
负债: |
|
— |
|
— |
||
负债总额 |
|
£ |
— |
|
£ |
— |
股东权益: |
|
|
|
|
||
普通股,面值0.0001英镑。20,000,000已发行和未偿还 |
|
2,000 |
|
2 |
||
额外实收资本 |
|
219,015 |
|
209,634 |
||
累计赤字 |
|
(196,457) |
|
(729) |
||
其他综合收入: |
|
|
|
|
||
外汇损益 |
|
(9) |
|
790 |
||
股东权益共计 |
|
24,550 |
|
209,697 |
||
总负债和股东权益 |
|
£ |
24,550 |
|
£ |
209,697 |
所附附注是这些财务报表的组成部分
F-23
GIO世界健康有限公司
业务说明
截至2022年12月31日和2021年12月31日止年度
|
英镑 |
|
英镑 |
|||
12/31/22 |
12/31/21 |
|||||
服务收入 |
|
£ |
— |
|
£ |
— |
收入 |
|
— |
|
— |
||
收益成本 |
|
— |
|
— |
||
毛利 |
|
£ |
— |
|
£ |
— |
公司费用 |
|
|
234 |
|||
专业费用 |
|
97,883 |
|
|
||
广告与营销 |
|
77,019 |
|
|
||
差旅费 |
|
10,433 |
|
|
||
一般和行政费用 |
|
10,393 |
|
495 |
||
营业费用 |
|
£ |
195,728 |
|
£ |
729 |
所得税前亏损 |
|
(195,728) |
|
(729) |
||
所得税费用 |
|
— |
|
— |
||
净损失 |
|
£ |
(195,728) |
|
£ |
(729) |
所附附注是这些财务报表的组成部分
F-24
GIO世界健康有限公司
股东权益变动表
截至2022年12月31日止年度
其他 |
合计 |
|||||||||||||
普通股 |
付费 |
累积 |
股东 |
|||||||||||
股票 |
金额 |
资本 |
赤字 |
股权 |
||||||||||
截至2021年9月20日的余额(初始) |
|
— |
|
£ |
— |
|
£ |
— |
|
£ |
— |
|
£ |
— |
发行普通股 |
|
20,000 |
|
2 |
|
— |
|
— |
|
2 |
||||
额外实收资本 |
|
— |
|
— |
|
209,634 |
|
— |
|
209,634 |
||||
货币换算调整数----上一期间 |
|
— |
|
— |
|
— |
|
— |
|
— |
||||
货币换算调整数-本期 |
|
— |
— |
|
— |
|
790 |
|
790 |
|||||
净损失 |
|
— |
|
— |
|
— |
|
(729) |
|
(729) |
||||
截至2021年12月31日的余额 |
|
20,000 |
|
£ |
2 |
|
£ |
209,634 |
|
£ |
61 |
|
£ |
209,697 |
发行普通股 |
|
19,980,000 |
|
— |
|
— |
|
— |
|
— |
||||
额外实收资本 |
|
— |
|
1,998 |
|
9,382 |
|
— |
|
11,380 |
||||
货币换算调整数----上一期间 |
|
— |
|
— |
|
— |
|
(790) |
|
(790) |
||||
货币换算调整数-本期 |
|
— |
|
— |
|
— |
|
(9) |
|
(9) |
||||
净损失 |
|
— |
|
— |
|
— |
|
(195,728) |
|
(195,728) |
||||
截至2022年12月31日的余额 |
|
20,000,000 |
|
£ |
2,000 |
|
£ |
219,015 |
|
£ |
(196,465) |
|
£ |
24,550 |
所附附注是这些财务报表的组成部分
F-25
GIO世界健康有限公司
现金流量表
2022年12月31日及2021年12月31日
|
英镑 |
|
英镑 |
|||
12/31/22 |
12/31/21 |
|||||
净损失 |
|
£ |
(195,728) |
|
£ |
(729) |
货币换算调整数 |
|
(9) |
|
790 |
||
为将净亏损与业务活动所用现金净额对账而作出的调整: |
|
|
|
|
||
预付存款 |
|
115,938 |
|
(125,783) |
||
经营活动所用现金净额 |
|
(79,798) |
|
(125,722) |
||
投资活动产生的现金流量 |
|
£ |
— |
|
£ |
— |
筹资活动产生的现金流量 |
|
|
|
|
||
上一年度货币调整 |
|
(790) |
|
— |
||
股东收益 |
|
11,380 |
|
209,636 |
||
筹资活动提供的现金净额 |
|
£ |
10,590 |
|
£ |
209,636 |
期初现金及现金等价物 |
|
£ |
83,914 |
|
£ |
0 |
期末现金及现金等价物 |
|
£ |
14,706 |
|
£ |
83,914 |
所附附注是这些财务报表的组成部分
F-26
业务的组织和性质
业务说明
本财务报表为于2021年9月20日注册成立的有限公司GIO World Health Limited(简称“本公司”)的财务报表。公司注册地址为伦敦文洛克路20-22号,地址为N1 7GU。
该公司的主要业务是推广干细胞治疗和产品,包括抗衰老疗法、活性化妆品产品、红细胞生产和新冠疫情治疗。该公司的目标是获得授权,在全球范围内使用其干细胞疗法,并销售干细胞相关产品。
2021年12月15日,公司与全球干细胞治疗与研究公司(简称“GIOSTAR”)签订了独家许可协议,独家使用GIOSTAR的某些干细胞方案和知识产权。
注2。陈述和持续关注的基础
本公司的财务报表是根据美国公认会计原则(“公认会计原则”)编制的,并以本公司的功能货币英镑列报。该公司采用权责发生制会计,并采用了12月31日的会计年度结束。
公司的财务报表是按照我们在截至2022年12月31日的财政期间报告的公认会计原则编制的。我们总结了我们最重要的会计政策。
新兴成长型公司地位
该公司是一家“新兴成长型公司”。经修订的1933年《证券法》(《证券法》)第2(a)节(经2012年《Jumpstart The Company’s Business Startups Act》(《JOBS法》)修订)的定义,《证券法》可以利用适用于非新兴成长型公司的其他上市公司的各种报告要求的某些豁免,包括但不限于不被要求遵守《萨班斯-奥克斯利法》第404节的审计师证明要求,在定期报告和代理声明中减少有关高管薪酬的披露义务,以及豁免就高管薪酬举行不具约束力的咨询投票和股东批准任何先前未获批准的金降落伞付款的要求。
此外,《JOBS法》第102(b)(1)节规定,在要求私营企业遵守新的或经修订的财务会计准则之前,新兴成长型企业不必遵守新的或经修订的财务会计准则。JOBS法案规定,公司可以选择退出延长的过渡期,并遵守适用于非新兴成长型公司的要求,但任何选择退出的选择都是不可撤销的。本公司已选择不选择退出这一延长的过渡期,这意味着当一项准则被发布或修订,而其对上市公司或私营公司的适用日期不同时,本公司作为一家新兴成长型公司,可以在私营公司采用新的或修订的准则时采用新的或修订的准则。这可能使公司未经审计的财务报表难以与另一家上市公司进行比较,因为所使用的会计准则可能存在差异。
在编制财务报表时使用估计数
按照公认会计原则编制财务报表,要求管理层作出估计和假设,这些估计和假设会影响资产和负债的呈报数额,以及在财务报表日披露或有资产和负债以及在每个报告期内呈报的净收入和支出数额。实际结果可能与这些估计数不同。
F-27
现金
本公司将所有购买之原到期日为三个月或更短的短期高流动性投资视为现金等价物。
收入确认
在截至2022年12月31日的期间内,公司的收入确认政策符合ASC 606“客户合同收入”的规定,该规定要求销售确认遵循以下五个步骤:(一)确定与客户签订的合同;(二)确定合同中的履约义务;(三)确定交易价格;(四)将交易价格分配给合同中的履约义务;(五)在实体履行履约义务时确认收入。
由于没有收入,公司没有属于ASC 606范围的重大合同资产或负债。
每股普通股净亏损----基本亏损和稀释亏损
关于每股收益的权威指导要求对所有资本结构复杂的实体的基本和稀释每股收益或亏损(“EPS”)进行双重列报,并要求对基本每股收益计算的分子和分母与稀释每股收益计算的分子和分母进行调节。基本每股收益不包括稀释;稀释每股收益反映了如果发行普通股的证券或其他合同被行使或转换为普通股,或导致发行普通股,然后分享实体的收益,则可能发生的稀释。
每股基本亏损的计算方法是将适用于普通股股东的净亏损除以该期间已发行普通股的加权平均数。稀释每股亏损反映了如果稀释性证券和其他发行普通股的合同被行使或转换为普通股或导致发行普通股,然后分享公司收益,可能发生的稀释,除非其影响是减少亏损或增加每股收益。
股票补偿
根据ASC第718号《补偿——股票补偿》(简称ASC 718),本公司根据授予日的公允价值计量基于股票的补偿安排的补偿成本,并在财务报表中确认员工需要提供服务的期间的成本。
截至2022年12月31日,没有发行或未偿还的股票奖励。
金融工具的公允价值
我们使用会计准则编纂(ASC)820,公允价值计量和披露中建立的公允价值层次对我们的金融资产和负债进行经常性估值。
ASC 820描述了可用于计量公允价值的三个层次的投入,如下:
第1级投入,包括相同资产或负债在活跃市场中的报价。
第二级投入,包括第一级投入以外的可观察投入,如类似资产或负债的报价;不活跃市场中相同或类似资产或负债的报价;或在资产或负债的整个期限内可观察或可由可观察市场数据证实的其他投入;以及
F-28
第3级投入,包括很少或根本没有市场活动支持的、对基础资产或负债的公允价值具有重要意义的不可观测投入。第3级资产和负债包括其公允价值计量采用定价模型、贴现现金流量方法或类似估值技术以及管理层的重大判断或估计确定的资产和负债。
所得税
公司根据ASC主题740“所得税”,采用资产负债法核算所得税。根据这一方法,所得税费用按下列数额确认:(一)当年应缴或可退还的税款;(二)因实体财务报表或纳税申报表中已确认的事项而产生的暂时性差异所产生的递延税款后果。递延所得税资产和负债采用预期在这些暂时性差异有望收回或结算的年份适用于应纳税所得额的已颁布税率计量。税率变动对递延所得税资产和负债的影响在包括颁布日期在内的期间的经营业绩中确认。如果根据现有的正面和负面证据的权重,递延所得税资产的一部分或全部很可能无法实现,则提供估值备抵以减少所报告的递延所得税资产。
ASC主题740.10.30澄清了企业财务报表中确认的所得税不确定性的会计处理,并规定了财务报表中确认和计量纳税申报表中已采取或预期将采取的税务状况的确认门槛和计量属性。ASC主题740.10.40提供了关于终止确认、分类、利息和罚款、中期会计、披露和过渡的指导。
最近颁布和采用的会计准则
财务会计准则委员会或其他标准制定机构不时发布新的会计公告,这些公告可能会对公司的会计和报告产生影响。公司认为,这些最近发布的会计公告和未来生效的其他权威指导意见不会对公司的会计或报告产生影响,也不会在实施时对公司的财务状况、经营成果和现金流量产生重大影响。
注3。持续关注
所附财务报表的编制假设本公司将持续经营。公司自成立以来一直亏损,截至2022年12月31日累计亏损195,728英镑。公司目前的流动资金有限,尚未完成建立稳定的收入来源的努力,足以支付较长时期的运营成本。除其他外,这些因素使人们对其能否继续作为一个持续经营的企业产生了很大的怀疑。财务报表不包括这些不确定因素可能导致的任何调整。公司今后将需要额外的融资,并正在采取各种战略来实现这一目标,包括从私募来源寻求股权融资和/或债务融资。尽管管理层相信,通过上述方法,它将能够获得必要的资金,使公司能够继续经营下去,但我们不能保证这些方法一定会成功。
管理层预计,在不久的将来,公司将依赖额外的投资资本来支付运营费用。除非公司能够筹集到资金,否则我们不能保证公司在此项或任何一项努力中取得成功,或在财务上变得可行并持续经营。
注4。股东"(赤字)
普通股
公司被授权发行无限数量的普通股,面值为0.0001英镑。截至2022年12月31日,发行在外的普通股为20,000,000股。
F-29
| ● | 2021年12月1日,TAG Partners Ltd.发行了20,000股公司普通股。 |
| ● | 2021年12月1日,GIOSTAR发行了80,000股公司普通股,支付了300,000,000美元的许可费,这与GIOSTAR向公司授权使用GIOSTAR的某些干细胞技术的协议有关。 |
| ● | 2022年6月20日,TAG Partners Ltd.的20,000股普通股在200:1反向分割后增至4,000,000股普通股。 |
| ● | 2022年6月20日,GIOSTAR的80,000股普通股在200:1反向分割后增至16,000,000股普通股。 |
实收资本
根据公司成立,截至2022年12月31日和2021年12月31日的金额分别为221,015英镑和209,636英镑,代表公司出资合伙人以现金认购股份的金额。
注5。预付费用
截至2022年12月31日和2021年12月31日,预付余额分别为9844英镑和125783英镑。这是为向公司提供服务而向律师存入的现金。
注6。承诺与或有事项
一旦公司开始根据与GIOSTAR的许可协议实现使用许可产品和服务的收入,公司有义务支付每年100,000.00美元的许可维持费,但是,支付此费用的义务应在公司成为并继续根据与GIOSTAR的许可协议从事许可产品和服务的商业销售、再许可或其他商业开发之日结束。
F-30
注7。后续事件
| ● | 2023年3月1日,根据GIOSTAR与本公司之间的许可协议的增编,GIOSTAR增发了1,000,000股普通股,使其在本公司的总持股达到17,000,000股普通股。 |
| ● | 2023年3月1日,TAG Partners Ltd.根据GIOSTAR与公司之间的许可协议增编,增发了200,000股普通股,使其在公司的总持股达到4,200,000股普通股。 |
| ● | 2023年3月1日,公司向GIOSTAR高级职员Deven Patel发行了1,900,000股普通股,此前GIOSTAR与公司签订了一份许可协议增编,以代替每年支付100,000美元的一半股份。 |
| ● | 2023年3月1日,公司向GIOSTAR高级管理人员Anand Shrivastava博士发行了1,900,000股普通股,此前GIOSTAR与公司签订了一份许可协议增编,以代替每年支付100,000美元的一半股份。 |
| ● | 2023年3月1日,公司向GIOSTAR的员工/承包商发行了总计327,400股普通股,作为对服务的忠诚补偿;这些普通股的市值为32.74英镑,基于发行之日的面值0.0001英镑。 |
| ● | 2023年3月1日,公司向非关联方Inonda Limited发行了1,000股普通股,用于未来的营销服务。这些股票在发行之日的面值为0.0001英镑,价值为0.10英镑。 |
| ● | 2023年4月26日,TAG Partners Ltd.将1,520,088股普通股无偿交还公司。交还本公司的股份现为库藏股。 |
2023年3月8日,公司与Apeiron Capital投资公司(“Apeiron”)签订了业务合并协议。交易完成后合并的上市公司将被命名为GIO World Health Holdings,Inc.,在拟议的交易中,该公司的估值为2.5亿美元的投资前企业价值。公司现有股东将保留其在交割后合并上市公司的100%股权,并将继续拥有交割后合并上市公司约80.83%的备考股权,假设Apeiron的公众股东不赎回,并且公司所有股东都参与交易。
本公司评估在期末日期之后直至财务报表可供发布之日发生的事件。因此,管理层在这些财务报表发布之日之前对后续事件进行了评估,并确定没有需要在这些财务报表中披露的后续事件。
F-31
附件A
执行副本
机密
商业合并协议
由和之间
APEIRON CAPITAL INVESTMENT CORP.,
作为买方,
APEIRON CAPITAL SPONSOR,LLC,
以买方代表的身份,
GIO世界健康有限公司,
作为公司,
本公司的股东,
作为卖方,
和
德文·帕特尔,
以卖方代表的身份,
截至2023年3月8日
目 录
页 |
|
A-2 |
|
A-2 |
|
A-2 |
|
A-2 |
|
A-4 |
|
A-4 |
|
A-4 |
|
A-4 |
|
A-5 |
|
A-5 |
|
A-5 |
|
A-5 |
|
A-5 |
|
A-5 |
|
A-6 |
|
A-6 |
|
A-6 |
|
A-7 |
|
A-7 |
|
A-8 |
|
A-8 |
|
A-8 |
|
A-8 |
|
A-8 |
|
A-9 |
|
A-9 |
|
A-9 |
|
A-9 |
|
A-9 |
|
A-9 |
|
A-10 |
|
A-10 |
|
A-10 |
|
A-11 |
|
A-11 |
|
A-11 |
|
A-11 |
|
A-11 |
|
A-12 |
|
A-12 |
|
A-12 |
|
A-13 |
|
A-14 |
|
A-14 |
|
A-14 |
|
A-14 |
|
A-14 |
|
A-16 |
|
A-17 |
A-i
页 |
|
A-18 |
|
A-18 |
|
A-19 |
|
A-19 |
|
A-20 |
|
A-21 |
|
A-22 |
|
A-22 |
|
A-23 |
|
A-23 |
|
A-24 |
|
A-24 |
|
A-24 |
|
A-24 |
|
A-24 |
|
A-25 |
|
A-25 |
|
A-25 |
|
A-25 |
|
A-25 |
|
A-25 |
|
A-26 |
|
A-26 |
|
A-26 |
|
A-26 |
|
A-27 |
|
A-27 |
|
A-27 |
|
A-27 |
|
A-27 |
|
A-27 |
|
A-28 |
|
A-30 |
|
A-32 |
|
A-32 |
|
A-33 |
|
A-33 |
|
A-33 |
|
A-34 |
|
A-35 |
|
A-35 |
|
A-37 |
|
A-37 |
|
A-38 |
|
A-38 |
|
A-39 |
|
A-39 |
|
A-39 |
|
A-40 |
|
A-40 |
|
A-40 |
|
A-40 |
|
A-41 |
A-ii
页 |
|
A-41 |
|
A-43 |
|
A-43 |
|
A-43 |
|
A-44 |
|
A-44 |
|
A-44 |
|
A-44 |
|
A-45 |
|
A-45 |
|
A-45 |
|
A-46 |
|
A-46 |
|
A-47 |
|
A-47 |
|
A-48 |
|
A-48 |
|
A-48 |
|
A-49 |
|
A-49 |
|
A-49 |
|
A-49 |
|
A-49 |
|
A-49 |
|
A-50 |
|
A-50 |
|
A-51 |
|
A-52 |
|
A-53 |
|
A-53 |
|
A-1 |
附件和附件索引 |
||
附件 |
|
说明 |
|
|
|
|
||
|
||
|
|
|
附件 |
|
说明 |
|
|
|
附件 A |
|
卖方合并的形式 |
附件 B |
|
投票协议的形式 |
附件 C |
|
锁定协议的形式 |
附件 D |
|
非竞争协定的形式 |
附件 E |
|
卖方登记权协议 |
A-iii
商业合并协议
本业务合并协议(本“协议”)是由(i)特拉华州公司Apeiron Capital Investment Corp.(连同其后继者,即“买方”)、(ii)特拉华州有限责任公司Apeiron Capital Sponsor,LLC(定义见下文)自交易结束之日起及之后作为买方股东(卖方及其各自的后继者和受让人除外)的代表,根据本协议的条款和条件(“买方代表”)、(iii)GIO World Health,Ltd.,于2023年3月8日签订的,根据英格兰和威尔士法律成立的私人公司(“公司”),(iv)在本协议签署之日已签立并交付本协议副本的本公司附件一所列的每一名股东,每一名股东均为公司内幕人士(定义见下文)(统称为“签署卖方”),(v)在登记声明(定义见下文)生效日期后签立并交付买方的本公司其他每一名股东,本公司与代表各方签署一份合并协议,其形式与本协议所附的附件 A基本相同(每一方均称为“卖方合并”),以成为本协议的一方,卖方合并协议以书面形式被接受,并由买方、本公司和代表各方签署和交付,卖方合并协议包含公司普通股股东确认已收到本协议所述交易的登记声明(统称为“合并卖方”,与签署卖方一起称为“卖方”),以及(vi)Deven Patel,根据本协议的条款和条件担任卖方代表(“卖方代表”)。买方、买方代表、本公司、卖方和卖方代表在本文中有时被单独称为“一方”,统称为“一方”。本文中使用的某些大写术语在本文的XI中定义。
简历:
A.本公司通过其子公司直接或间接从事干细胞相关技术的业务,以提供产品、治疗和服务;
签署卖方,以及在签署和交付本协议时,加入卖方,希望向买方出售,而买方希望从签署卖方,以及在签署和交付本协议时,加入卖方,购买这些卖方拥有的公司所有已发行和未发行的股份以及任何其他股权,以换取新发行的买方A类普通股(“股票交易所”),根据本协议规定的条款和条件,并根据适用法律的适用条款;
在签署和交付本协议的同时,作为公司内部人的签署卖方分别与买方和公司签订了一份投票协议,其形式作为附件 B附于本协议(各自称为“投票协议”);
在执行和交付本协议的同时,作为重要卖方的签字卖方各自与买方和买方代表签订了一份锁定协议,其形式作为附件 C附于本协议(每一份为“锁定协议”),每一份锁定协议自交易结束时起生效;
在执行和交付本协议的同时,某些签署卖方各自签订了一份有利于买方、本公司和每一所涵盖的其他缔约方(如其中所定义)的《不竞争和不招标协议》,其形式作为附件 D附于本协议(每一份为“非竞争协议”),该《非竞争协议》自交易结束时起生效;以及
F.在签署和交付本协议的同时,某些签署的卖方已分别在买方和卖方之间签订了一份登记权协议,该协议的副本作为附件 E附在本协议之后(“卖方登记权协议”),卖方登记权协议应于交易结束时生效。
因此,鉴于以上所列的前提已纳入本协议,如同下文已充分阐述一样,以及本协议所载的陈述、保证、契约和协议,以及其他良好和有价值的代价,兹确认这些代价的收到和充分程度,并打算在此受法律约束,本协议双方同意如下:
A-1
第一条
股票交易
1.1股份买卖。在交割时,卖方应根据本协议的条款和条件,向买方出售、转让、转让、转让和交付,买方应向卖方购买、收购和接受卖方拥有的公司所有已发行和未发行的股本(统称为“已购股份”),不受任何留置权(适用的证券法对转售的潜在限制除外)。
1.2交换考虑。在交易结束时,根据本协议的条款和条件,作为所购股份的对价,卖方应有权合计向其发行若干股买方A类普通股(“交易所股份”),其总价值等于(“交易所对价”)(a)250,000,000美元(250,000,000美元),乘以(b)等于(“所购股份百分比”)(i)所购股份总数的百分比,除以(ii)本公司已发行及未发行股本股份总数。各卖方应按其所购股份占本公司已发行及未发行股本股份总数的百分比(该百分比为各卖方的“按比例股份”),按比例获得其在交易所的股份。即使本协议另有相反规定,买方将不会凭藉本协议或本协议所设想的交易而发行买方A类普通股的任何零头,而每名本应有权获得买方A类普通股的零碎股份的人(在将买方A类普通股的所有零碎股份合并后,否则将由该人收到),则须将向该人发行的买方A类普通股的股份数目,按总数四舍五入至买方A类普通股最接近的整股。此外,在交割后,在遵守本协议规定的条款和条件的情况下,如果符合第1.3节规定的适用股价目标,收益卖方应有权从买方获得收益股票作为额外对价。为免生疑问,公司证券的持有人将不会根据本协议或与本协议有关而收取任何代价,除非他们是本协议项下的卖方,或作为签署卖方或联合卖方,然后只就他们所拥有的已发行和未发行的公司普通股收取代价。
1.3收益。
(a)在交割后,在符合本协议规定的条款和条件的情况下,盈利卖方应有权按比例获得最多相当于5,400万股(54,000,000股)的买方A类普通股的额外股份乘以所购股份百分比(但须在交割后对股份分割、股息、合并、资本重组等进行公平调整,包括计入此类股份被交换或转换成的任何股本证券)(“盈利股份”),作为买方根据买方A类普通股在交割后五(5)年期间(即“盈利期”)的表现所作的额外对价。盈利卖方收取盈利股份的权利应按以下方式归属和到期并可发行:
(i)如果买方A类普通股的VWAP等于或超过每股12.50美元(根据股票分割、股票股息、重组和资本重组进行调整)(“一级股票价格目标”)在盈利期间的任何三十(30)个交易日内的二十(20)个交易日,则根据本协议的条款和条件,盈利卖方有权获得一定数量的盈利股票,该数量等于1500万股(15,000,000股)乘以所购股票百分比;
(ii)如果买方A类普通股的VWAP等于或超过每股15.00美元(根据股票分割、股票股息、重组和资本重组进行调整)(“二级股票价格目标”)在盈利期间的任何三十(30)个交易日内的二十(20)个交易日,则盈利卖方有权获得额外的盈利股票数量,该数量等于1800万股(18,000,000股)乘以所购股票百分比;和
(iii)如果买方A类普通股的VWAP等于或超过每股17.50美元(根据股票分割、股票股息、重组和资本重组进行调整)(“第三级股价目标”,连同第一级股价目标和第二级股价目标,“股价目标”)在盈利期内任何三十(30)个交易日内的二十(20)个交易日,则根据本协议的条款和条件,盈利卖方有权获得剩余盈利股份,数额为2,100万(21,000,000)乘以所购股份百分比。
如果在盈利期间未达到适用的股价目标,盈利卖方无权获得盈利股份的适用部分。为免生疑问,Earnout股份只可在
A-2
与盈利期内首次实现适用的股价目标有关,且已实现且已发行盈利股票的任何后续实现股价目标的卖方均无权获得盈利股票。任何股价目标的实现应被视为包括任何较低股价目标的实现,买方应一起发行可归属于每个股价目标的盈利股份(在此基础上,该等较低的股价目标应被视为已实现,且在随后实现该等较低股价目标时不再支付盈利股份)。
(b)尽管有上述规定,如果在盈利期内(i)买方可能发生控制权变更,或(ii)买方根据《交易法》第13e-3条进行“私有化”交易,在(i)或(ii)条中的任何一种情况下,在适用的交易中,以每股明示或暗示的价格(“触发交易价格”),其数额等于或高于先前未归属于盈利股的股价目标(“触发事件”),则在符合协议条款和条件的情况下,若触发交易价格超过先前未实现的任何股票价格目标,且相关的收益股票先前未归属于任何收益股票,则收益股票卖方有权按比例获得该收益股票的收益股票。
(c)买方首席财务官(“首席财务官”)应在盈利期内的每个交易日监测买方A类普通股的VWAP,并在实际可行的情况下尽快(无论如何在盈利期内每个月结算周年结束后的十(10)个工作日内),由首席财务官编写并向卖方代表和买方代表(各自称为“代表方”)提交一份书面声明,一份“收益报表”),其中列出(i)买方A类普通股在随后结束的每个月周年期间和前一个月期间的每个交易日的VWAP,以及(ii)在前两(2)个月周年期间是否实现了股价目标。同样,在可行的情况下,无论如何,在触发事件发生后的五(5)个工作日内,财务主任将尽快向每一代表缔约方发送一份收益声明,表明触发事件已经发生,并附上该触发事件的详细信息。每一代表缔约方在收到收益报表后将有十(10)个工作日对其进行审查,每一代表缔约方及其代表可就其审查过程中出现的与收益报表有关的问题或对收益报表的不同意见向首席财务官及相关买方和公司人员和顾问提出询问,买方和公司应提供与此相关的合理合作。如果任何一代表方对收益说明有任何异议,该代表方应向买方(提请财务主任注意)和另一代表方提交一份说明,说明其反对意见(详细程度合理)。如果代表方未在每份盈利报表交付之日后十(10)个工作日内提交上述书面报表,则该代表方将放弃其对盈利报表以及在盈利期间的适用部分(以及股价目标是否已实现)内买方A类普通股VWAP的计算或触发事件是否已按报表所述发生提出异议的权利。如代表缔约方在该十(10)个工作日期间内提交了此种书面陈述,则代表缔约方应本着诚意进行谈判,在其后十(10)个工作日期间内解决任何此种反对意见。如果代表缔约方未能在这十(10)个工作日期间内达成最后解决办法,则代表缔约方将根据任何一方的书面请求,将争议提交独立专家根据第1.3(d)节最后解决争议。
(d)如果与收益说明有关的争议按照本第1.3节提交独立专家最后解决,双方将遵循本第1.3(d)节规定的程序。卖方代表和买方代表同意,如果独立专家提出要求,就独立专家将作出的决定签署一份合理的约定书。独立专家的所有费用和开支,以及代表方为解决独立专家在本协议项下的任何争议而支付的所有其他自付费用和开支,将由买方承担。独立专家将只对截至独立专家通知日期仍有争议的问题作出决定,独立专家的决定将完全基于并符合本协定的条款和条件。独立专家的决定将完全基于买方代表和卖方代表就这类争议物品向独立专家所作的陈述,而不是基于独立专家的独立审查,独立专家通过选择买方代表或卖方代表在各自陈述中提出的适用立场来确定每一问题;但这种陈述将被视为包括任何工作文件和记录,代表缔约方向独立专家提交的与此种陈述有关的陈述或类似材料,以及应独立专家的要求向独立专家提交的任何材料。卖方代表和买方代表在向独立专家提交争议物品后,将尽其合理努力尽快作出各自的陈述。作为陈述的一部分,每一代表缔约方将有权对另一代表缔约方的陈述以及独立专家的任何问题和请求作出答复。在决定任何事项时,独立专家将受本协定各项规定的约束,包括本第1.3节。双方的意图是,独立专家在此方面的活动不是(也不应被视为或被视为)仲裁程序或
A-3
类似的仲裁程序,不应遵循任何正式的仲裁规则(包括有关程序和发现的规则)。代表缔约方将要求独立专家在其参与后四十五(45)天内作出决定,或在此之后尽快在提交代表缔约方的书面陈述中作出决定,该决定将是最终的、结论性的、不可上诉的,并对本协议下的所有目的(欺诈或明显错误除外)具有约束力。
(e)如根据本条第1.3条作出最后裁定,即盈利卖方有权因已达到股价目标或由于已发生触发事件而收取任何盈利股份,则该等盈利股份的适用部分将于作出上述最后裁定后到期,而买方须在其后十(10)个营业日内将该等股份交付盈利卖方,而每名盈利卖方须按比例收取该等盈利股份的盈利股份。
(f)交割后(包括盈利期间),买方及其子公司,包括目标公司,将有权根据买方及其子公司的业务要求经营各自的业务。在交易结束后(包括盈利期间),各买方及其子公司,包括目标公司,将被允许自行决定对其业务、组织、人员、会计惯例和其他业务方面作出改变,包括可能对买方A类普通股的VWAP和盈利卖方赚取盈利股份的能力产生影响的行动,而Earnout卖方将无权要求赔偿因上述决定而导致的Earnout股份的全部或任何部分的损失或其他损害。尽管有上述规定,买方不应并应促使其子公司(包括目标公司)不采取或不采取任何恶意的行动,其主要目的是避免、降低或阻止实现或实现股价目标。
(g)TAG Partners Ltd.,作为签署卖方,代表其本身及其受让人和受让人,特此(i)确认并同意,其及其受让人和受让人将无权就其所购买的股份收取本协议项下收益股份的任何部分,而收益股份将转由本协议项下的所有其他卖方支付,并且(ii)不可撤销地放弃任何可能的权利,就盈利股份或其未能收到任何盈利股份或其根据本协议购买的股份所导致的不成比例的较低代价而提出的索赔或诉讼。
1.4经修订的采购人组织文件。自交易结束时起,买方须将其公司注册证书及附例修订及重述,使其格式须由买方及本公司各自合理行事(统称为“经修订的买方组织文件”),并须将买方组织文件修订为(i)规定买方的名称须更改为“GIO World Health Holdings,Inc.”,或由买方及本公司共同同意的其他名称,(ii)按照第6.15条订定交割后买方委员会的规模和结构;(iii)将买方A类普通股更名为“买方普通股”;(iv)删除和更改公司注册证书中与买方作为空白支票公司的地位有关的某些规定;(v)在其他方面适合在适用的国家交易所上市的上市公司。
1.5交出购买的股份。在交割时,各卖方将向买方交付一份就其所购公司普通股正式签立的股份转让表格,以及代表所购公司普通股的证书(“公司证书”)。如任何公司证明书已遗失、被盗或毁坏,以代替向买方交付公司证明书,卖方可向买方交付一份遗失证明书的法定声明,以及买方和本公司合理接受的形式和实质内容的损失赔偿(“遗失证明书法定声明”);买方可酌情酌情在声明中包括一项规定,即遗失证明书的所有人,被窃或被毁的公司证明书交付一笔保证书,保证书须按其合理指示的款额交付,作为对买方或公司就公司证明书所代表的公司股份被指称遗失、被盗或被毁而提出的任何申索的弥偿。
1.6某些协议的终止。在不限制第9.2节的规定的情况下,本公司和卖方在此同意,自交易结束时起,本公司与任何卖方或卖方之间就本公司的股本股份而授予股东或股东、表决权或类似协议的任何协议,均应自动全部终止,并不再具有任何效力。此外,每一卖方和本公司特此免除双方根据任何上述协议或本公司组织文件对本协议和附属文件所设想的交易承担的任何义务,以及双方未能遵守与本协议和附属文件所设想的交易有关的任何条款。
1.7采取必要行动。如在交割后的任何时间,为实现本协议的宗旨,并赋予买方对本公司或其任何附属公司的所有资产、财产、权利、特权、权力及专营权的全部权利、所有权和权益,以及拥有和/或占有本公司或其任何附属公司的所有资产、财产、权利、特权、权力及专营权,则本公司的高级人员及董事
A-4
买方以本公司或其任何附属公司的名义并代表本公司或其任何附属公司获得充分授权,可采取一切必要或可取的合法行动,以达到该等目的或作为,只要该等行动不违反本协议。
第二条
收盘
2.1结束。在满足或放弃第七条规定的条件的前提下,本协议所设想的交易的完成(“交割”)应在买方律师Ellenoff Grossman & Schole,LLP(“EGS”)的办公室进行,地址为1345 Avenue of the Americas,New York,NY 10105,以电子签字的方式远程交换,日期和时间由买方和公司商定,日期不迟于第二个日期(2nd)在本协议所列的所有交割条件得到满足或放弃后的营业日,或在买方和本公司可能商定的其他日期、时间或地点(包括远程)(实际举行交割的日期和时间为“交割日期”)。
第三条
买方代表和认股权证
除(i)买方在本协议日期向本公司和签署卖方交付的披露时间表(“买方披露时间表”)中规定的情况外,这些披露时间表的编号与它们所指的本协议的章节编号相对应,或(ii)可通过EDGAR在SEC网站上查阅的SEC报告,买方在本协议日期和截止收盘时向本公司和卖方陈述和保证如下:
3.1组织和地位。买方是一家根据特拉华州法律正式成立、有效存在并具有良好信誉的公司。买方拥有一切必要的公司权力和权力,拥有、租赁和经营其财产,并按目前的经营方式经营其业务。买方具有适当的资格或执照,并具有良好的信誉,可在其拥有、租赁或经营的财产的性质或其经营的业务的性质使其有必要取得此种资格或执照的每个法域内经营业务,但未能取得此种资格或执照的情况除外,如果未能取得此种资格,就个别或总体而言,没有也不会合理地预期对买方具有重大意义。买方迄今已向本公司提供了其组织文件的准确和完整的副本,目前有效。买方在任何重大方面均未违反其组织文件的任何规定。
3.2授权;具有约束力的协议。买方拥有一切必要的法人权力和权力,以执行和交付本协议及其作为当事方的每一份附属文件,履行买方在本协议项下和本协议项下的义务,并完成在此设想的交易,但须获得必要的买方股东批准。本协议及其作为当事方的每份附属文件的执行和交付,以及本协议所设想的交易的完成,因此(a)已得到买方董事会的正式和有效授权,(b)除必要的买方股东批准外,除本协议其他条款所规定的以外,没有其他公司程序,买方必须授权执行和交付本协议及其作为当事方的每一份附属文件,或完成本协议所设想的交易,从而完成。本协议已经生效,买方作为当事方的每份附属文件在交付时,应由买方正式有效地签署和交付,并假定本协议及其他当事方对本协议及此类附属文件的适当授权、签署和交付,即构成或在交付时应构成买方的有效和具有约束力的义务,可根据协议条款对买方强制执行,但其可执行性可能因适用的破产、无力偿债而受到限制的除外,重组和暂停执行的法律和其他普遍适用的法律影响到债权人权利的普遍强制执行,或影响到任何适用的诉讼时效或任何有效的抵销抗辩或反请求的强制执行,以及衡平法补救或救济(包括具体履行的补救)受制于可寻求此种救济的法院的酌处权(统称为“可执行性例外”)。
3.3政府批准。除附表3.3另有说明外,买方在执行、交付或履行本协议及其作为当事方的每份附属文件或完成本协议所设想的交易时,无须取得或取得任何政府当局的同意或取得任何政府当局的同意,但(a)根据反垄断法,(b)本协议所设想的提交文件除外,(c)就本协议所设想的交易向纽约证券交易所或另一国家交易所或证券交易委员会提交的任何文件,(d)《证券法》、《交易法》和/或任何州的“蓝天”证券法及其下的规则和条例的任何适用要求,以及(e)如果未能获得或作出此种同意,或作出此种文件或通知,不会合理地预期会对买方产生重大不利影响。
A-5
3.4不违反。除附表3.4另有说明外,买方签立和交付本协议及其作为当事方的每一份附属文件,完成本协议及本协议所设想的交易,以及买方遵守本协议及本协议的任何规定,不会(a)与买方组织文件的任何规定相冲突或违反,(b)在取得本协议第3.3节所指的政府当局的同意,而本协议所指的等待期已届满的情况下,及该等同意或放弃的任何先决条件已符合、抵触或违反适用于买方或其任何财产或资产的任何法律、命令或同意,或(c)(i)违反、抵触或导致违反,(ii)构成违约(或因通知或时间流逝而构成违约的事件),(iii)导致终止、撤回、暂停、取消或修改,(iv)加速买方根据,(v)导致根据,(vi)引起根据以下各项作出付款或提供补偿的义务,(vii)导致对买方的任何财产或资产产生任何留置权,(viii)引起取得任何第三方同意的义务或向任何人提供任何通知的义务,或(ix)使任何人有权宣布违约、行使任何补救措施、要求回扣、退款、罚款或更改交货时间表、加速到期或履行、取消、终止或修改任何条款下的任何权利、利益、义务或其他条款,任何买方材料合同的条件或规定,但与上述(a)、(b)或(c)项中任何一项的偏离不会合理地预期会对买方产生实质性不利影响的情况除外。
3.5资本化。
(a)授权买方发行111,000,000股股本,每股面值0.0001美元,其中100,000,000股为买方A类普通股,10,000,000股为买方B类普通股,1,000,000股为买方优先股。截至本协议日期已发行和尚未发行的买方证券载于附表3.5(a)。截至本协议签署之日,买方优先股没有已发行或未发行的股票。买方普通股的所有已发行股份均获得正式授权、有效发行、全额支付和不可评估,并且不受任何购买选择权、优先购买权、优先购买权、认购权或任何类似权利的约束,也不违反DGCL、买方组织文件或买方参与的任何合同的任何规定。未发行的买方证券均未违反任何适用的证券法。
(b)除附表3.5(a)或附表3.5(b)所列的情况外,没有(i)尚未行使的期权、认股权证、看跌期权、认购期权、可转换证券、优先认购权或类似权利,(ii)具有一般投票权的债券、债权证、票据或其他债务,或可转换或可交换为具有此类权利的证券,或(iii)认购或其他任何性质的权利、协议、安排、合同或承诺(本协议及附属文件除外),(A)与买方已发行或未发行的股份有关,或(B)有义务买方发行、转让、交付或出售或安排发行、转让、交付,出售或购回任何可转换为或可交换为该等股份的期权或股份或证券,或(C)责成买方就该等股本股份授予、延长或订立任何该等期权、认股权证、认购、认购或其他权利、协议、安排或承诺。除了就延期(“延期赎回”)或截止赎回(任何延期赎回或截止赎回、“赎回”)或本协议中明文规定的对公众股东进行的任何赎回以外,买方没有未清偿的义务回购、赎回或以其他方式收购买方的任何股份,或提供资金对任何人进行任何投资(以贷款、出资或其他形式)。除附表3.5(b)所列情况外,并无任何股东协议、有表决权信托或其他协议或谅解是买方就任何股份的表决权而作为当事方的。
(c)附表3.5(c)披露买方截至本协定日期的所有债务。买方的债务不包含对(i)提前偿还任何此类债务、(ii)买方产生债务或(iii)买方对其财产或资产授予任何留置权的能力的任何限制。
(d)自买方成立之日起,除本协议规定的情况外,买方未就其股份宣布或支付任何分配或股息,也未回购、赎回或以其他方式取得其任何股份,买方董事会也未授权上述任何事项。
3.6证券交易委员会备案和买方财务。
(a)自首次公开发行以来,买方已向证券交易委员会提交了根据《证券法》和(或)《交易法》要求提交或提交的所有表格、报告、附表、声明、登记声明、招股说明书和其他文件,以及对这些文件的任何修订、重述或补充,并将在本协议日期之后提交所有此类表格、报告、附表、声明和其他要求提交的文件。除通过EDGAR在证券交易委员会网站上可查到的情况外,买方已按向证券交易委员会提交的表格向公司交付了副本。
A-6
以下所有事项的证券交易:(一)从买方被要求提交此种表格的第一年开始的买方每个财政年度的10-K表格年度报告;(二)买方提交此种报告的每个财政季度的10-Q表格季度报告;(三)所有其他表格、报告、登记声明,买方自上述第(i)条提及的第一个财政年度开始以来向SEC提交的招股说明书和其他文件(初步材料除外)(上述第(i)、(ii)和(iii)条提及的表格、报告、注册声明、招股说明书和其他文件,无论是否可通过EDGAR获得,统称为“SEC报告”)和(iv)根据《交易法》(A)规则13a-14或15d-14和(B)18 U.S.C. § 1350(SOX第906节)要求的所有证明和声明,涉及上述第(i)条提及的任何报告(统称为“公开证明”)。除非根据美国证券交易委员会于2021年4月12日发布的《特殊目的收购公司(SPAC)认股权证的会计和报告考虑因素员工声明》以及美国证券交易委员会的相关指导意见,对(A)买方将买方认股权证作为权益而非负债的历史会计处理进行任何修改(包括对买方财务报表(定义见下文)或美国证券交易委员会报告的任何必要修订或重述),(B)买方将买方已发行的可赎回股份的会计处理或分类为临时性的,而非永久性的,由于SEC工作人员的相关陈述或买方审计师的建议或要求,或(C)买方在本协议签署之日之后与SEC工作人员有关非现金会计事项的任何其他指导有关的历史或未来会计(第(A)至(C)条,统称为“SEC SPAC会计变更”),可能需要的股权,SEC报告(x)在所有重大方面都是根据《证券法》和《交易法》的要求(视情况而定)编制的,而其中的规则和条例和(y)没有,在其各自的生效日期(对于根据《证券法》要求提交的登记声明的SEC报告)和提交给SEC时(对于所有其他SEC报告),包含任何对重要事实的不真实陈述,或根据做出这些陈述的情况,未说明其中要求陈述的或做出这些陈述所必需的重要事实,而不是误导,公开证书自各自提交之日起均为真。双方承认并同意,因SEC SPAC会计变更而对买方财务报表或SEC报告进行的任何重述、修订或其他修改,均应被视为对本协议而言不重要。在本第3.6节中,“文件”一词应被广义地解释为包括证券交易委员会的规则和条例所允许的向证券交易委员会提供、提供或以其他方式提供文件或信息的任何方式。截至本协议签署之日,除附表3.6(a)、(A)买方单位、买方A类普通股和买方公开认股权证在纽约证券交易所上市外,(B)买方尚未收到纽约证券交易所关于此类买方证券继续上市要求的任何书面缺陷通知,(c)就买方实体暂停、禁止或终止该买方证券在纽约证券交易所的报价的任何意图而言,金融业监管局没有对买方采取任何待决行动,或据买方所知,没有对买方构成任何威胁,而且(d)该买方证券符合纽约证券交易所所有适用的公司治理规则。
(b)除证券交易委员会的任何SPAC会计变更外,证券交易委员会报告中所载或以引用方式纳入的买方财务报表和说明(“买方财务报表”)在所有重大方面均公允地反映了买方在这些财务报表所述各期间的财务状况和经营成果、股东权益变动和现金流量,所有这些都符合(一)在所述各期间一致适用的公认会计原则方法和(二)S-X条例或S-K条例,视情况而定(附注中可能说明的情况除外,以及在适用的S-X条例或S-K条例允许的范围内,在未经审计的季度财务报表中省略附注和审计调整的情况除外)。
(c)除任何SEC SPAC会计变更外,或除在买方财务报表中反映或保留的范围外,买方没有发生任何未在买方财务报表中充分反映或保留或未在买方财务报表中提供的按照GAAP要求反映在资产负债表中的负债或义务,但在正常业务过程中自买方成立以来发生的按照GAAP要求反映在资产负债表中的负债除外。
3.7未作某些改动。截至本协议签署之日,除附表3.7所列情况外,买方(a)自成立以来,除其成立、公开发行其证券(及相关的非公开发行)、公开报告和寻找首次公开发行说明书所述的首次业务合并(包括对目标公司的调查以及本协议的谈判和执行)及相关活动外,未进行任何其他业务;(b)自2021年12月31日以来,未对买方产生任何重大不利影响。
3.8遵守法律。买方目前和自其成立以来一直遵守对其适用的所有法律和其业务的开展,但不遵守情理上不会产生重大不利影响的不遵守情事除外
A-7
对买方的影响,并且买方尚未收到书面通知,声称买方在任何重大方面违反了适用法律。
3.9行动;命令;许可证。据买方所知,不存在任何有待采取或可能采取的、可合理预期会对买方产生重大不利影响的重大行动。买方未对任何其他人提起任何实质性诉讼。买方不受任何政府当局的任何重要命令的约束,也不受任何此类命令的待决。买方持有一切必要的材料许可证,以合法开展其目前经营的业务,并拥有、租赁和经营其资产和财产,所有这些都具有充分的效力和效力,除非未能持有该同意书或该同意书不具有充分的效力和效力,将不会合理地预期会对买方产生重大的不利影响。
3.10税收和报税表。
(a)买方已及时提交或促使及时提交其要求提交的所有重要报税表,这些报税表在所有重要方面都是准确和完整的,并已支付、收取或扣留,或促使支付、收取或扣留所有需要支付、收取或扣留的重要税款,但已按照公认会计原则在买方财务中建立适当准备金的税款除外。附表3.10(a)列出买方提交或须提交报税表的每一管辖区。没有针对买方的任何税款的审计、审查、调查或其他程序待决,也没有以书面形式通知买方针对买方的任何拟议税务索赔或评估(但在每一种情况下,买方财务报表中已根据公认会计原则为其建立足够准备金或数额不重大的索赔或评估除外)。除准许的留置权外,对买方任何资产的任何税款都没有留置权。买方没有任何尚未完成的豁免或任何适用的诉讼时效的延长,以评估任何实质性的税额。买方并无要求延长提交任何报税表的期限或延长任何报税表所显示的应缴税款的期限。
(b)自成立之日起,买方没有(i)改变任何税务会计方法、政策或程序,但法律变更所要求的除外;(ii)作出、撤销或修订任何重大税务选择;(iii)提交任何经修订的报税表或要求退款的申索;或(iv)订立任何影响或以其他方式解决或损害任何重大税务责任或退款的结案协议。
3.11雇员和雇员福利计划。买方并不(a)有任何受薪雇员,或(b)维持、赞助、供款于任何福利计划,或根据该计划承担任何法律责任。
3.12属性。买方不拥有、许可或以其他方式拥有任何重要知识产权的任何权利、所有权或权益。买方不拥有或租赁任何重要的不动产或重要的个人财产。
3.13材料合同。
(a)除附表3.13(a)所列情况外,除本协议及附属文件外,并无任何买方为其当事方的合同,或其任何财产或资产可能受其约束、约束或影响的合同,而该合同(i)产生或施加的赔偿责任超过200000美元,(ii)买方不得在未支付重大罚款或终止费的情况下提前不到六十(60)天通知取消,或(iii)在任何重大方面禁止、阻止、限制或损害买方目前进行的业务的任何业务惯例,买方取得的任何重大财产,或在任何重大方面限制买方从事目前由其经营的业务或与任何其他人竞争的能力(每一方均称为“买方重大合同”)。所有买方材料合同均已提供给本公司,但证交会报告所展示的合同除外。
(b)就每份买方材料合同而言:(i)买方材料合同是在正常业务过程中公平订立的;(ii)买方材料合同在所有重大方面对买方以及据买方所知对其他当事方都是合法、有效、有约束力和可强制执行的,并且具有充分的效力和效力(但在每一种情况下,此种强制执行可能受到可强制执行例外的限制);(iii)买方在任何重大方面没有违约或违约,(四)据买方所知,任何买方材料合同的其他任何一方在任何重要方面均未发生因时间的推移或通知的发出或两者兼而有之将构成买方在任何重大方面的违约或违约,或允许另一方终止或加速履行该合同;以及(四)任何买方材料合同的任何其他一方在任何重大方面均未发生违约或违约,也未发生因时间的推移或给予
A-8
通知或两者均构成该另一方的违约或违约,或允许买方终止或加速任何买方材料合同。
3.14与附属公司的交易。附表3.14列出了截至本协议签署之日存在的合同和安排的真实、正确和完整的清单,根据这些合同和安排,买方与任何(a)买方的现任或前任董事、高级职员或雇员或附属公司,或上述任何一项的任何直系亲属之间存在任何现有或未来的负债或义务,或(b)记录或受益拥有买方截至本协议签署之日未偿还股本的百分之五(5%)以上。
3.15投资公司法。自本协议签订之日起,买方不是经修订的1940年《投资公司法》(《投资公司法》)所指的“投资公司”,即由“投资公司”直接或间接“控制”或代表“投资公司”行事的人。
3.16发现者和经纪人。除附表3.16所列明的情况外,任何经纪、发现人或投资银行家均无权根据买方或代表买方作出的安排,就本协议所设想的交易,从买方、目标公司或其任何关联公司收取任何经纪、发现人或其他费用或佣金。
3.17交易所股份的所有权。根据第一条向卖方发行和交付的所有交换股份,在该等交换股份发行和交付时,除适用的证券法、任何适用的锁定协议和任何卖方产生的任何留置权所产生的限制外,均应全额支付且不可评估,且不受任何留置权的限制,根据本协议发行和出售该等交换股份将不受任何优先购买权或优先购买权的约束或产生任何优先购买权。
3.18某些商业惯例。
(a)买方或其任何代表均未(i)将任何资金用于与政治活动有关的非法捐款、馈赠、娱乐或其他非法开支,(ii)向外国或国内政府官员或雇员、外国或国内政党或竞选活动非法付款,或违反1977年《美国反海外腐败法》或任何其他当地或外国反腐败或贿赂法的任何规定,(iii)作出任何其他非法付款,或(iv)自买方成立以来,直接或间接地,给予或同意给予任何客户、供应商、政府雇员或其他在任何实际或拟议的交易中有能力帮助或阻碍买方或协助买方的人任何数额的非法礼物或类似利益。
(b)买方的业务在任何时候都在实质上遵守所有适用法域的洗钱法规、根据这些法规制定的规则和条例以及任何政府当局颁布、管理或执行的任何相关或类似的规则、条例或准则,而且据买方所知,没有任何涉及买方的行动尚未完成,也没有任何威胁。
(c)买方或其任何董事或高级管理人员,或据买方所知,代表买方行事的任何其他代表目前均未被列入特别指定的国民或其他被封锁的人员名单,或目前受到美国财政部外国资产管制办公室(“OFAC”)实施的任何美国制裁的任何其他人员,且买方在过去五(5)个财政年度内未直接或间接使用任何资金,也未向任何子公司、合资伙伴或其他人出借、出资或以其他方式提供此类资金,与OFAC制裁的任何其他国家的任何销售或业务有关,或为资助目前受OFAC制裁或违反美国制裁的任何人的活动而进行的任何销售或业务。
3.19保险。附表3.19列出买方持有的与买方或其业务、财产、资产、董事、高级职员及雇员有关的所有保单(按保单号码、保险人、保险期间、保险金额、年度保费及保单种类),其副本已提供予本公司。所有此种保险单下的所有应付和应付保费均已及时支付,买方在其他方面实质上遵守此种保险单的条款。所有这类保险单都是完全有效的,而且据买方所知,任何这类保险单都不存在威胁终止或保费大幅增加的情况。买方没有提出任何保险索赔。买方均已向其保险人报告了合理预期会导致索赔的所有索赔和未决情况,除非未报告此种索赔不会合理地可能对买方产生重大不利影响。
A-9
3.20独立调查。买方已对目标公司的业务、经营结果、前景、状况(财务或其他方面)或资产进行了独立调查、审查和分析,并承认已为此目的向其提供了充分的查阅目标公司的人员、财产、资产、房地、簿册和记录以及其他文件和数据的渠道。买方承认并同意:(a)在作出订立本协议及完成本协议所设想的交易的决定时,买方完全依赖其本身的调查,以及本协议(包括公司披露附表的有关部分)及根据本协议交付买方的任何证明书所载的本公司及卖方的明示陈述及保证,以及本公司或卖方为登记声明提供的资料或代表本公司或卖方提供的资料,卖方或其任何代表均对目标公司、卖方或本协议作出任何陈述或保证,但本协议(包括公司披露附表的相关部分)或根据本协议交付给买方的任何证书中明确规定的除外,或就本公司或代表本公司为注册声明提供的信息作出的除外。
3.21信托账户。截至本报告所述之日,信托账户中至少有15,300,000美元。在交割前,除根据《信托协议》、《买方组织文件》和《首次公开发行说明书》的规定外,不得释放信托账户中的任何资金。信托账户中的金额投资于符合《投资公司法》颁布的第2a-7条规定的某些条件的美国政府证券或货币市场基金。买方迄今已履行了其根据信托协议所需履行的所有重大义务,并且并未发生重大违约或违约,并且据买方所知,没有发生任何事件,而在适当通知或时间流逝或两者兼而有之的情况下,该事件将构成信托协议项下的此种违约或违约。信托协议具有充分的效力和效力,是买方以及买方所知的受托人的一项法律、有效和有约束力的义务,可根据其条款强制执行,但须遵守可执行性例外规定。除与任何延期有关的必要范围外,本信托协议在任何方面均未被终止、否定、撤销、修正或补充或修改,并且据买方所知,不考虑此类终止、否定、撤销、修正、补充或修改。没有单独的合同、附函或其他安排(无论是书面的还是不书面的,明示或默示)将导致买方提交或提供的证券交易委员会报告中对信托协议的描述在任何重要方面不准确,或使任何人(根据买方组织文件和首次公开发行承销商就递延承销佣金选择赎回买方A类普通股股份的公众股东除外)有权在企业合并结束前获得信托账户中收益的任何部分。截至本报告所述之日,买方没有任何理由认为信托账户资金使用的任何条件不会得到满足,或在截止日期无法向买方提供信托账户中的可用资金。没有关于信托账户的待决行动。买方没有从信托账户中释放任何资金,只是根据信托协议从信托账户赚取的任何利息收入中支付税款,以及公共股东因修改买方组织文件以延长其完成业务合并的最后期限而赎回买方A类普通股。自交易结束时起,买方根据《买方组织文件》解散或清算的义务终止,买方不应根据《买方组织文件》因完成本合同所设想的交易而解散和清算买方资产的任何义务。在交易结束后,买方的任何股东都无权或无权从信托账户中收取任何款项,除非这些股东按照买方组织文件的规定,选择根据任何赎回办法,将其所持买方A类普通股股份投标赎回。
3.22提供资料。买方所提供或将提供的任何资料,均未明示列入或以提述方式纳入,最终亦未列入或以提述方式纳入:(a)任何有关表格8-K的现行报告,以及任何有关的证物或任何其他报告、表格,就本协议或任何附属文件所设想的交易向任何政府当局或证券交易所作出的登记或其他备案;(b)登记声明;或(c)就本协议所设想的交易的完成或(a)至(c)所指明的任何文件的任何修订而向买方股东和/或潜在投资者发出的邮寄或其他分发,在提交、提供、邮寄或分发(视情况而定)时,载有对重要事实的任何不实陈述,或忽略陈述根据作出这些陈述的情况而须在其中陈述或为作出这些陈述而必须陈述的任何重要事实,而不具误导性。买方所提供或将提供的任何资料,在提交或分发时(如适用的话)均不会包含任何有关重要事实的不实陈述,或略去陈述任何根据作出这些陈述的情况而须在其中陈述或作出这些陈述所必需的任何重要事实,而不是误导,而这些资料或将由买方提供以明确列入或以引用方式纳入任何签署新闻稿、签署文件、结束新闻稿及结束文件。尽管如此,买方并不就本公司、卖方或其任何附属公司所提供或代表本公司、卖方或其任何附属公司所提供的任何资料作出任何陈述、保证或契约。
A-10
3.23无其他申述。除买方在本条第三款(经买方披露附表修订)或附属文件中明示的陈述和保证外,买方或代表买方的任何其他人均不就买方或其业务、经营、资产或负债,或本协议或任何其他附属文件所设想的交易作出任何明示或默示的陈述或保证,买方在此明确否认任何其他陈述或保证,无论是否由买方子公司或其任何代表默示或作出。除买方在本条第三款(经《买方披露附表》修订)或附属文件中明确作出的陈述和保证外,买方在此明确表示不对向本公司、卖方或其各自的任何代表(包括买方的任何代表可能已或可能已向本公司、卖方或其各自的任何代表提供的任何陈述、保证、预测、预测、声明或信息(口头或书面)承担任何责任和义务,包括关于买方业务的可能成功或盈利的任何陈述或保证。
第四条
本公司之代表及授权书
除本公司于本协议日期交付买方的披露附表(“本公司披露附表”)所载明的情况外,本公司于本协议日期及截止日期向买方作出如下声明及保证:
4.1组织和地位。本公司是一家根据英格兰和威尔士法律正式成立、有效存在并具有良好信誉的公司,拥有一切必要的公司权力和权力,拥有、租赁和经营其财产,并经营其目前经营的业务。本公司的每一附属公司均为正式成立、有效存在并在其组织管辖权的法律之下具有良好信誉的公司或其他实体,并拥有一切必要的公司权力和权力,拥有、租赁和经营其财产,并按目前的经营方式经营其业务。每一目标公司在其成立为法团或注册为法团的司法管辖区,以及在其经营业务或经营业务的彼此司法管辖区,均具有适当的资格或执照,只要其拥有、租赁或经营的财产的性质或其经营的业务的性质使此种资格或执照成为必要,除非未能取得此种资格或执照对目标公司整体而言没有、也不会合理地预期个别或总体上具有重大意义。附表4.1列出目标公司有资格经营业务的所有司法管辖区,以及目标公司经营业务所使用的除其法定名称以外的所有名称。本公司已向买方提供其组织文件和各子公司组织文件的准确和完整的副本,每一份都已修订至今,并已生效。目标公司在任何重大方面均未违反其组织文件的任何规定。
4.2授权;具有约束力的协议。本公司拥有一切必要的法人权力和权力,以执行和交付本协议及本公司作为或被要求作为其中一方的每一份附属文件,履行本公司根据本协议及根据本协议所承担的义务,并完成本协议及本协议所设想的交易。本协议及本公司作为或须作为其中一方的每份附属文件的签立和交付,以及本协议所设想的交易的完成,(a)已获本公司董事会按照本公司的组织文件、英格兰及威尔士的法律妥为和有效地授权,本公司或其任何股东为其当事人的任何其他适用法律或任何合同,或本公司或其证券受其约束的任何其他适用法律或合同,以及(b)本公司无须进行任何其他公司程序,以授权执行和交付本协议及本公司为其当事人的每一份附属文件,或完成本协议及本协议所设想的交易。本协议已经生效,而本公司作为或被要求作为其中一方的每一份附属文件,在本公司交付、妥为有效地签立和交付时,并假定本协议及任何该等附属文件由本协议及本协议的其他各方适当授权、签立和交付,即构成本公司的法律、有效和有约束力的义务,在可执行性例外规定的限制下,可根据本协议的条款对本公司强制执行。公司董事在一次正式召集并举行的会议上通过决议,决定(i)本协议和股票交易所以及本协议所设想的其他交易对公司及其股东是可取的、公平的,并且符合公司及其股东的最佳利益;(ii)根据英格兰和威尔士的法律批准本协议和股票交易所以及本协议所设想的其他交易。
4.3资本化。
(a)本公司获授权发行25,348,400股公司普通股,所有该等股份均已发行及尚未发行。没有公司普通股以库存形式持有。所有已发行和尚未发行的公司普通股均已获正式授权和有效发行,已缴足股款且不可评税,且未违反任何购买行为而发行
A-11
选择权、优先购买权、优先购买权、认购权或英格兰和威尔士法律、任何其他适用法律、公司组织文件或公司作为当事方或受其约束的任何合同的任何类似权利。所有已发行和未发行的公司股份的法定(注册)和实益拥有人载于附件一,所有公司股份均由附件一所列的人拥有,除根据《公司组织文件》和适用的证券法施加的留置权外,没有任何其他留置权。本公司并无其他类别的股份或股本证券获授权或已发行,或将在收市后立即发行。
(b)不存在公司可转换证券、优先购买权或优先购买权或优先要约权,也不存在公司或据公司所知,其任何股东是公司任何股本证券的一方或受其约束的任何合同、承诺、安排或限制,无论这些证券是否尚未发行。本公司不存在未偿付或授权的股权增值、虚拟股权或类似权利。本公司并无表决权信托、代理、股东协议或任何其他有关本公司股权表决权的协议或谅解。除《公司组织文件》所列的情况外,公司并无回购、赎回或以其他方式取得公司的任何股本权益或证券的未履行的合约义务,公司亦没有就公司的股本证券向任何人授予任何登记权。本公司的所有证券均已按照所有适用的证券法授予、发售、出售和发行。由于本协议所设想的交易的完成,本公司的任何股权均不可发行,与本公司的任何权益、认股权证、权利、期权或其他证券有关的任何权利均不得加速或以其他方式触发(无论是在归属、可行权、可兑换或其他方面)。
(c)自公司成立以来,除《公司财务》所披露的情况外,公司并无就其股本权益宣布或支付任何分派或股息,亦无回购、赎回或以其他方式取得公司的任何股本权益,而公司董事会亦无授权上述任何一项。
4.4子公司。附表4.4列出了本公司各附属公司的名称,就各附属公司而言(a)其组织管辖权,(b)其授权股份或其他股权(如适用),(c)已发行和未发行股份或其他股权的数量及其记录持有人和实益拥有人,以及(d)其根据《守则》和任何州或适用的非美国税法(如有)被视为公司或被忽视的实体的税务选择。本公司每一附属公司的所有未偿付股本证券均得到正式授权和有效发行、全额支付和不可评估(如适用),并按照所有适用的证券法提供、出售和交付,并由本公司或其附属公司中的一个或多个拥有,不存在任何留置权(该附属公司的组织文件规定的任何留置权除外)。除任何附属公司的组织文件外,本公司或其任何附属公司在本公司任何附属公司的股权的表决权(包括表决权信托或代理人)方面没有任何合同是其中的一方或受其约束。本公司的任何附属公司并无任何尚未行使或已获授权的期权、认股权证、权利、协议、认购、可转换证券或承诺,而该等期权、认股权证、认股权证、认股权证、认股权证、认股权证、认股权证、认股权证、认股权证、认股权证、认股权证、认股权证、认股权证、认股权证、认股权证、认股权证、认股权证、认股权证本公司没有任何附属公司授予的未偿付的股权增值、虚拟股权、利润参与或类似权利。本公司的任何附属公司在向其股东作出任何分配或股息或偿还欠另一目标公司的任何债务的能力方面,不论根据合约、命令或适用法律,均无任何限制。除附表4.4所列附属公司的股本权益外,本公司并不拥有或有权直接或间接收购任何人的股本权益或以其他方式控制任何人。本公司或其附属公司均不参与任何合营、合伙或类似安排。本公司或其附属公司并无向任何其他人提供资金或作出任何投资(以贷款、出资或其他形式)的未完成合约义务。
4.5政府批准。除附表4.5另有说明外,任何目标公司在执行、交付或履行本协议或任何附属文件或完成本协议所设想的交易时,无须取得或取得任何政府当局的同意,亦无须取得或取得目标公司与任何政府当局的同意,但(a)本协议所明确设想的提交文件,(b)依据反托拉斯法或(c)如未能取得或作出该等同意,或未能作出该等提交文件或通知,则无须取得或取得该等政府当局的同意,个别或整体而言,对目标公司整体或其各自履行本协议或附属文件所规定的义务或完成本协议所设想的交易的能力,或在任何情况下,对目标公司在任何重大方面产生或合理地预期会产生不利影响。
4.6不违反。除附表4.6另有说明外,公司(或任何其他目标公司(如适用的话)签立及交付本协议及任何目标公司须为或须为其中一方或受其他约束的每一份附属文件,以及目标公司完成本协议所设想的交易,从而
A-12
任何目标公司遵守本协议及其任何条款,将不会(a)与任何目标公司的组织文件的任何条款相冲突或违反,(b)在取得本协议第4.5节所指的政府当局的同意、本协议所指的等待期已过,以及该等同意或放弃的任何先决条件已获满足、与适用于任何目标公司或其任何财产或资产的任何法律、命令或同意相冲突或违反的情况下,或(c)(i)违反、冲突或导致违反,(ii)构成以下情况下的失责(或经通知或时间推移或两者均会构成失责的事件):(iii)导致终止、撤回、暂停、取消或修改;(iv)加速任何目标公司根据以下情况所规定的履行;(v)导致根据以下情况所规定的终止或加速履行;(vi)导致根据以下情况作出付款或提供补偿的任何义务;(vii)导致对任何目标公司的任何财产或资产产生任何留置权,(viii)引起任何义务以取得任何第三方的同意或向任何人提供任何通知,或(ix)给予任何人宣布违约、行使任何补救、要求回扣、退款、罚款或更改交货时间表、加速到期或履行、取消、终止或修改任何公司物料合约的任何条款、条件或条文所规定的任何权利、利益、义务或其他条款的权利、利益、义务或其他条款,但任何偏离上述(a)、(b)或(c)条的情况除外,而该等偏离并不会个别地或合计地发生,对目标公司整体或其各自履行本协议或附属文件所规定的义务或完成本协议或本协议所设想的交易的能力具有或合理地预期会在任何重大方面产生不利影响。
4.7财务报表。
(a)如本文所用,“公司财务”一词是指(i)根据第6.4(a)节提交的2022年公司财务报表,以及(ii)目标公司2021财政年度的经审计合并财务报表(包括任何相关附注),包括目标公司截至2021年12月31日(“最后资产负债表日”)的经审计合并资产负债表,以及相关的经审计合并损益表、股东权益变动表和现金流量表,由符合PCAOB资格的审计师根据GAAP和PCAOB标准进行审计。公司已向买方提供了公司财务报表的真实和正确的副本。公司财务报表(一)准确反映目标公司截至上述时间和期间的账簿和记录;(二)按照公认会计原则编制,在所有相关期间和期间一致适用(但未经审计的报表不包括公认会计原则要求的脚注披露和其他列报项目,不包括在性质或金额上不具有重大意义的年终调整);(三)遵守《证券法》和证交会相关规则和条例的所有适用会计要求,(四)在所有重大方面公允列报目标公司截至各自日期的综合财务状况以及目标公司在所示期间的综合经营业绩和现金流量。目标公司从未受《交易法》第13(a)和15(d)条的报告要求约束。
(b)每一目标公司保持准确的帐簿和记录,反映其资产和负债,并保持适当和充分的内部会计控制,以便合理保证:(i)该目标公司不保留任何账外账目,且该目标公司的资产仅按照该目标公司的管理指示使用;(ii)交易是在管理层授权下进行的;(iii)交易记录是必要的,以便编制该目标公司的财务报表,并保持对该目标公司资产的问责制,(iv)只有根据管理层的授权,才允许进入该目标公司的资产;(v)定期将该目标公司的资产报告与现有资产进行比较,并核实实际数额;(vi)准确记录账目、票据和其他应收款及存货,并执行适当和适当的程序,以便及时及时地收回账目、票据和其他应收款。目标公司的所有财务账簿和记录在所有重要方面都是完整和准确的,并按照过去的惯例和适用的法律在正常过程中保持。目标公司没有发生或卷入任何涉及管理层或在目标公司财务报告内部控制中发挥重要作用的其他雇员的重大欺诈行为。在过去五(5)年中,没有任何目标公司或其代表收到关于任何目标公司的会计或审计做法、程序、方法或方法或其内部会计控制的任何书面投诉、指控、断言或要求,包括关于任何目标公司从事有问题的会计或审计做法的任何重大书面投诉、指控、断言或要求。
(c)目标公司没有任何负债。
(d)除附表4.7(d)所列的情况外,任何目标公司均不受任何负债或债务(不论是否须反映在按照公认会计原则编制的资产负债表上)的约束,但以下情况除外:(i)在公司财务报表所载的截至最近资产负债表日期的公司及其附属公司的综合资产负债表上得到充分反映或保留,或在公司财务报表所载的截至最近资产负债表日期的综合资产负债表上得到规定,或(ii)不重要,且在最近资产负债表之后发生
A-13
与以往惯例相符的正常经营过程中的日期(违反任何合同或违反任何法律的责任除外)。
(e)由本公司或代表本公司向买方或其代表交付的关于目标公司的所有财务预测,都是本着诚意使用本公司认为合理的假设编制的。
4.8没有某些改动。除附表4.8所列的情况外,自2021年12月31日起,每间目标公司(a)只在符合以往惯例的正常经营过程中经营业务,(b)没有受到重大不利影响,及(c)没有采取任何行动,或没有承诺或同意采取任何第6.2(b)条所禁止的行动(但不使附表6.2生效),而该等行动是在本条例的日期或之后未经买方同意而采取的。
4.9遵守法律。自2018年1月1日以来,目标公司没有或曾经有任何重大冲突或重大不遵守、重大违约或违反,也没有任何目标公司收到任何书面通知,或据公司所知,任何重大冲突或不遵守、重大违约或违反其或其任何财产、资产、雇员、业务或运营受或曾经受其约束或影响的任何适用法律的口头通知。
4.10公司许可证。每一目标公司(及其雇员,在法律上须获政府当局发牌,才能就其受雇于任何目标公司而履行其职责),均持有一切必要的许可证,以在所有重要方面合法地进行其目前进行和目前预期进行的业务,并拥有、租赁和经营其资产和财产(统称为“公司许可证”)。本公司已向买方提供所有物料公司许可证的真实、正确及完整副本,而所有物料公司许可证均列于附表4.10。所有公司许可证均已全面生效,任何公司许可证均不会被暂停或取消,或据公司所知,不会受到威胁。目标公司并无在任何重要方面违反任何公司许可证的条款,亦无目标公司接获任何书面通知,或据公司所知,接获任何与撤销或修改任何公司许可证有关的行动的口头通知。
4.11诉讼。除附表4.11所述者外,并无(a)任何性质的诉讼目前正待处理,或据公司所知是威胁(而在过去五(5)年内并无任何此类诉讼或据公司所知是威胁);或(b)任何目标公司、其现任或前任董事、高级人员或股东在(a)或(b)任何情况下或针对任何目标公司、其现任或前任董事、高级人员或权益持有人的(但须有任何涉及该等董事的诉讼,目标公司的高级职员或股东必须与目标公司的业务、股本证券或资产)、其业务、股本证券或资产有关。附表4.11所列项目,如最终决定对目标公司不利,则不会对任何目标公司个别或整体产生重大不利影响。在过去五(5)年内,目标公司的现任或前任高级人员、高级管理人员或董事均未因任何重罪或涉及欺诈的罪行被起诉、起诉、逮捕或定罪。
4.12材料合同。
(a)附表4.12(a)列出了一份真实、正确和完整的清单,而公司已向买方提供了一份真实、正确和完整的清单(包括口头合同的书面摘要),其中列出了任何目标公司为当事方的每份合同,或任何目标公司或其任何财产或资产受其约束或影响的每份合同(每份合同须在附表4.12(a)“公司重要合同”中列出):
(i)载有限制任何目标公司(A)在任何业务范围内或在任何地理区域内与任何人竞争,或销售、提供任何服务或产品或招揽任何人的能力的契诺,包括任何不竞争契诺、雇员及顾客不招揽契诺、排他性限制、优先购买权或最优惠定价条款,或(B)购买或取得任何其他人的权益;
(ii)涉及任何合营企业、利润分享、合伙企业、有限责任公司或与任何合伙企业或合营企业的成立、创立、经营、管理或控制有关的其他类似协议或安排;
(iii)涉及以任何商品、证券、票据、资产、汇率或指数(不论有形或无形的)为基础,包括货币、利率、外币及指数,进行交易、场外交易或其他掉期、限额、下限、项圈、期货合约、远期合约、期权或其他衍生金融工具或合约;
A-14
(iv)任何未偿还本金超过20万美元的目标公司的债务(不论由任何资产招致、承担、担保或担保)的证据;
(v)涉及直接或间接(以合并或其他方式)收购或处置资产总值超过$ 200,000(在符合以往惯例的正常经营过程中除外)或任何目标公司或另一人的股份或其他股本权益;
(vi)涉及与任何其他人的合并、合并或其他业务合并,或涉及收购或处置任何其他实体或其业务或重要资产,或涉及出售任何目标公司、其业务或重要资产;
(vii)根据其条款,单独或与所有相关合同一起,要求目标公司根据这些合同或合同每年至少支付200000美元或合计收取500000美元;
(viii)规定目标公司有义务在本协议日期之后继续提供第三方超过200000美元的赔偿或债务担保;
(ix)任何目标公司与目标公司的任何董事、高级人员或雇员之间的合约(在正常业务过程中与符合以往惯例的雇员订立的随意雇佣安排除外),包括所有竞业禁止、遣散及补偿协议或任何有关人士;
(x)规定目标公司有义务作出任何超过200000美元的资本承诺或支出(包括依据任何合资企业);
(xi)涉及在本协议日期前三(3)年内订立的重大和解协议,或任何目标公司根据该协议有未履行的义务(惯例保密义务除外);
(xii)向另一人(另一目标公司或任何目标公司的任何经理、董事或高级人员除外)提供授权书;
(xiii)涉及由任何目标公司、向任何目标公司或从任何目标公司(现成软件除外)开发、拥有、发牌或使用任何重要知识产权;
(xiv)根据适用的证券交易委员会规定须与注册声明一并提交,或根据《证券法》S-K规例第601(b)(1)、(2)、(4)、(9)或(10)条规定须由公司作为S-1表格的证物提交,犹如公司是注册人一样;或
(xv)在其他方面对任何目标公司是重要的,而且在正常业务过程之外,并不是上文第(i)至(xiv)条所描述的。
(b)除附表4.12(b)所披露的情况外,就每份公司物料合约而言:(i)该公司物料合约在各方面均对合约的目标公司一方有效及具约束力及可强制执行,并在公司知悉的情况下对合约的另一方均有效及有效(但在每宗个案中,(ii)本协议所设想的交易的完成不会影响任何公司重大合同在任何重大方面的有效性或可执行性;(iii)目标公司在任何重大方面没有违约或失责,亦没有发生任何事件,而随着时间的推移或通知的发出或两者的发出,会构成任何目标公司在该公司重大合同下的重大违约或失责,或容许该公司的另一方终止或加速履行;(iv)据公司所知,该公司重大合同的任何其他方均未在任何重大方面违约或失责,亦未发生任何事件,而随着时间的推移或通知的发出或两者的同时发生,会构成该其他方在该公司重大合同项下的重大违约或失责,或允许任何目标公司终止或加速履行;(v)目标公司未收到任何书面文件,或据公司所知,口头通知任何该等公司物料合约的任何一方有意终止该公司物料合约或修订该合约的条款,但在正常业务过程中作出的不会在任何重要方面对目标公司造成不利影响的修改除外;及(vi)目标公司并无放弃任何该等公司物料合约下的任何重要权利。
A-15
4.13知识产权。
(a)附表4.13(a)(i)列出:(i)目标公司拥有或许可的所有美国和外国注册专利、商标、版权和互联网资产及应用程序,或目标公司为其所有人、申请人或受让人的目标公司以其他方式使用或持有供其使用的所有专利、商标、版权和应用程序(“公司注册知识产权”),具体说明每一项目(如适用):(A)项目的性质,包括标题;(B)项目的所有人;(C)项目的发行或登记或已提交发行或登记申请的司法管辖区;(D)项目的发行,登记或申请编号及日期;及(ii)目标公司拥有或声称拥有的所有未登记的重要知识产权。附表4.13(a)(ii)列出了所有知识产权许可、分许可和其他协议或许可(“公司知识产权许可”)(“收缩包装”、“点击包装”除外)。以及以合理条款向公众提供的软件的“现成”软件协议和其他协议(统称为“现成软件”),这些协议一般不超过每年5万美元的许可、维护、支持和其他费用(统称为“现成软件”),这些协议不要求列出,尽管此类许可是本文所用的“公司知识产权许可”),根据这些协议,目标公司是被许可人或以其他方式被授权使用或实践任何知识产权,并说明(A)所适用的知识产权被许可、分许可或使用,以及(B)任何专利使用费,目标公司应支付的许可费或其他补偿(如果有的话)。每一目标公司拥有、不受任何留置权(许可留置权除外)约束的所有知识产权,并拥有使用、出售、许可、转让或转让该目标公司目前使用、许可使用或持有以供使用的所有知识产权,以及该目标公司以前使用或许可使用的所有知识产权的有效和可执行的权利,但作为公司知识产权许可标的的知识产权除外。任何由专利或待决专利申请组成的公司注册知识产权项目都不能识别所有相关的发明人,就公司注册知识产权中的每一项专利和专利申请而言,目标公司已从每一发明人获得有效的发明转让。除附表4.13(a)(iii)所列的情况外,所有公司注册知识产权完全由适用的目标公司拥有,没有义务就该公司注册知识产权向任何第三方支付使用费、许可费或其他费用,或以其他方式向该公司注册知识产权入账,而该目标公司已将所有公司注册知识产权的转让记录在任何适用的知识产权局或政府当局。
(b)每一目标公司均拥有有效和可强制执行的许可证,可使用适用于该目标公司的公司知识产权许可证所涵盖的所有知识产权。公司知识产权许可证包括目前经营目标公司所需的所有许可证、分许可证和其他协议或许可。各目标公司均已履行公司知识产权许可证对其施加的所有义务,并已支付了迄今为止所需的所有款项,而该目标公司并不是,据公司所知,也不是违反或违约的任何其他方,亦不存在任何因通知或时间流逝而构成违约或两者兼而有之的事件。目标公司继续使用公司知识产权许可证标的知识产权的方式与目前使用的方式相同,不受任何目标公司的任何适用许可证的限制。所有版权、专利、商标及互联网资产的注册,如由目标公司拥有或独家授权予任何目标公司,均属有效及信誉良好,所有所需费用及维护费及/或续期费均已缴付,且无任何行动待决,而所有注册任何版权、专利及商标的申请均属待决及信誉良好,所有申请均无任何质疑(适用的知识产权局或政府机构在提交及检控该等申请的正常过程中可能发出的行政行动除外)。作为公司注册知识产权中任何专利或专利申请的指定所有人的每一目标公司,或该目标公司的代表,已就起诉此类专利或专利申请向任何适用的知识产权政府机构披露了所有重要的现有技术。任何要求目标公司将其在目标公司根据该合同开发的任何知识产权上的所有权利转让给任何人的合同,目标公司都不是该合同的当事方。
(c)附表4.13(c)列出了目标公司作为许可人的所有许可、分许可和其他协议或许可(每一项均为“出境知识产权许可”),并就每一项此类出境知识产权许可,说明(i)所适用的知识产权许可,(ii)此类出境知识产权许可下的被许可人,以及(iii)应支付给目标公司的任何使用费、许可费或其他补偿(如果有的话)。每一目标公司均已履行外发知识产权许可证对其施加的所有义务,而该目标公司并无违反或失责,亦据公司所知,该目标公司并无违反或失责,亦无发生任何因通知或时间推移或两者均会构成失责的事件。
(d)对目标公司目前拥有、许可使用、使用或持有以供使用的任何知识产权的有效性、可执行性、所有权或使用权、出售、许可或分许可,或以其他方式与之相关的任何诉讼,都没有待决或据公司所知,对目标公司构成威胁,也没有任何合理的诉讼依据。目标公司并无收到任何书面通知或据公司所知的口头通知或申索,声称或暗示任何侵犯、挪用、侵犯、稀释或未经授权使用任何其他人的知识产权的行为正在或可能正在发生,或已经或可能已经发生
A-16
任何目标公司的活动,亦据公司所知,并无合理的基础。任何目标公司都不是其中一方的命令,也不受该命令的其他约束:(i)限制目标公司使用、转让、许可或强制执行目标公司拥有的任何知识产权的权利;(ii)限制目标公司的业务开展,以容纳第三人的知识产权;(iii)授予任何第三人对目标公司拥有的任何知识产权的任何权利,而不是外发知识产权许可证。目标公司目前并无在任何重要方面侵犯或曾经侵犯、挪用或侵犯任何其他人的任何知识产权,而该等知识产权与目标公司拥有或声称拥有的任何知识产权的拥有、使用或许可有关,或据公司所知,与目标公司各自业务的经营有关。据本公司所知,目前或过去五(5)年内,没有任何第三方在任何重要方面侵犯、挪用或以其他方式侵犯任何目标公司(“公司知识产权”)所拥有、许可、许可或以其他方式使用或持有的任何知识产权。
(e)目标公司(及其各自的附属公司)的所有高级人员、董事、雇员及独立承建商(或其各自的附属公司)(x)已向目标公司转让,或(y)截至交割时将已向目标公司转让由该等人士为目标公司进行或交付的任何工作、贡献或服务所产生或产生的所有知识产权,并在适用情况下,公司注册知识产权的所有该等转让均已记录在案。目标公司的现任或前任高级人员、雇员或独立承包商均未声称对目标公司拥有的任何知识产权拥有任何所有权权益。据公司所知,没有违反目标公司有关保护公司知识产权的政策或做法,也没有违反与目标公司所拥有的知识产权有关的任何保密或保密合同。据本公司所知,任何目标公司的雇员并无根据任何合约或受任何命令所规定的义务,而该合约或命令会实质上干扰该雇员为促进目标公司的利益而作出的最大努力,或会与任何目标公司目前进行或预期进行的业务有实质上的冲突。每个目标公司都采取了合理的安全措施,以保护公司知识产权的保密性、保密性和价值。
(f)据公司所知,没有任何人未经授权获得目标公司拥有的第三方信息和数据(包括个人身份信息),也没有对这些信息或数据的安全性、保密性或完整性造成任何其他重大损害,而且据公司所知,目标公司没有收到任何书面或口头投诉,涉及任何此类信息或数据的不当使用、披露或安全方面的破坏。各目标公司在所有重大方面遵守了与隐私、个人数据保护、收集、处理和使用个人信息有关的所有适用法律和合同要求,并遵守了其自身的隐私政策和准则。目标公司的业务经营没有、也没有侵犯任何第三人的隐私权或公开权,或构成适用法律规定的不公平竞争或贸易惯例。
(g)本协定所设想的任何交易的完成,不会因(i)任何规定目标公司拥有的知识产权的许可证或其他使用的合同,或(ii)任何公司知识产权许可证而导致实质性违反、实质性修改、取消、终止、中止或加速任何与源代码有关的付款或释放。交割后,公司应获准通过其子公司直接或间接行使目标公司在此类合同或公司知识产权许可证下的所有权利,其程度与目标公司在未发生本协议所设想的交易的情况下本可行使的权利相同,而无需支付任何额外金额或对价,而不是在没有此类交易的情况下目标公司本应支付的持续费用、特许权使用费或付款。
4.14税款和报税表。
(a)每一目标公司已经或将要及时提交或促使及时提交其要求提交的所有联邦、州、地方和外国纳税申报表(考虑到所有可用的延期),这些纳税申报表在所有重要方面都是真实、准确、正确和完整的,并且已经支付、收取或扣留,或促使支付、收取或扣留所有需要支付、收取或扣留的税款,但已在公司财务中建立充分准备金的税款除外。每一目标公司在所有重要方面均遵守了与税务有关的所有适用法律。
(b)在目标公司未提交纳税申报表表明其须或可能须受该司法管辖区征税的情况下,该司法管辖区的政府当局目前没有对目标公司采取任何待决行动,或据公司所知没有对目标公司采取任何威胁行动。
(c)没有任何目标公司正接受任何税务当局的审计,或已获任何税务当局以书面通知,或据公司所知,已获任何税务当局口头通知,任何此种审计正在考虑或有待进行。没有索赔、诉讼、评估
A-17
或据公司所知,就任何税项而对目标公司提出的审计、检查、调查或其他诉讼,而目标公司并无收到任何针对其提出的税务申索或评估的书面通知(在每宗个案中,已在公司财务中建立足够储备金的申索或评估除外)。
(d)对任何目标公司的资产征税,除准许的留置权外,没有留置权。
(e)每一目标公司已收取或扣留其目前需要收取或扣留的所有税款,所有这些税款均已支付给有关政府当局,或留在适当账户中,以备将来到期支付。
(f)任何目标公司都没有任何尚未完成的豁免或延长适用的诉讼时效,以评估任何税额。目标公司并无要求延长提交任何报税表的时间,或延长任何报税表所显示的应缴税款的时间。
(g)目标公司没有对会计方法作出任何改变(除非法律的改变要求),也没有收到任何税务当局的裁定,或与任何税务当局签署协议,而这些裁定是合理地预期在结束后会对其税收产生重大影响的。
(h)任何目标公司都不对另一人(另一目标公司除外)的税款承担任何责任或潜在责任,而这些税款没有充分反映在公司财务报表中(一)根据任何适用的税法,(二)作为受让人或继承人,或(三)通过合同、赔偿或其他方式(不包括在正常经营过程中订立的主要目的不是分享税款的商业协议)。任何目标公司均不是任何税务赔偿协议、分税协议或分税协议或类似协议、安排或惯例(不包括在正常经营过程中订立的商业协议,其主要目的不是分税)的一方或受其约束,这些协议或惯例将对任何目标公司在截止日期后的任何期间具有约束力的税款(包括预定价协议、结算协议或与任何政府当局有关的其他协议)。
(i)目标公司并无就任何税项向任何政府当局提出要求,亦无受任何私人函件裁决、技术意见备忘录、结账协议或类似裁决、备忘录或协议的约束,亦无任何该等要求尚未落实。
4.15不动产。附表4.15载有一份完整而准确的清单,列明目标公司目前为经营目标公司业务而租赁或转租或以其他方式使用或占用的所有处所,以及所有现行租约、租约担保、与之有关的协议和文件,包括所有修订、终止、修改或豁免(统称“公司不动产租约”),以及每份公司不动产租约下的现行年租金和租期。本公司已向买方提供每一份本公司不动产租赁的真实和完整的副本,如为任何口头公司不动产租赁,则提供该公司不动产租赁的重要条款的书面摘要。公司不动产租赁根据其条款是有效的、有约束力的和可执行的,并具有充分的效力和效力。据本公司所知,并无任何会构成目标公司或任何其他方在本公司任何不动产租赁下的失责的事件(不论是否有通知、时间流逝或两者兼有,或任何其他事件的发生或发生)发生,而目标公司亦无收到任何有关该等情况的通知。目标公司没有拥有或曾经拥有任何不动产或不动产的任何权益(公司不动产租赁的租赁权益除外)。
4.16个人财产。附表4.16列出了目标公司目前拥有、使用或租赁的每一项个人财产,其账面价值或公允市场价值超过25000美元(25000美元),并在适用的情况下列出了一份租赁协议、租赁担保、担保协议和其他有关协议的清单,包括对这些协议的所有修订、终止和修改或放弃(“公司个人财产租赁”)。除附表4.16所列的情况外,所有该等个人财产物品均处于良好的运作状况及维修状态(合理损耗,但与该等物品的使用年限相符的情况除外),并适合其拟用于目标公司的业务。每一目标公司现在经营或目前拟经营的业务的经营,并不取决于目标公司以外的人的个人财产的使用权,但目标公司拥有、租赁、许可或以其他方式与目标公司订立合同的个人财产除外。本公司已向买方提供每一份本公司个人财产租赁的真实及完整副本,如属任何口头的本公司个人财产租赁,则向买方提供该等本公司个人财产租赁的重要条款的书面摘要。本公司的个人财产租赁根据其条款是有效、有约束力和可强制执行的,并具有充分的效力和效力。据公司所知,并无任何事件发生
A-18
(不论是否有通知、时间的流逝或两者兼而有之,或任何其他事件的发生或发生)将构成目标公司或任何其他方在公司任何个人财产租赁项下的违约,而目标公司并无收到任何该等条件的通知。
4.17资产的所有权和充足性。每一目标公司对其所有资产拥有良好和可销售的所有权或有效的租赁权益或使用权,不存在除(a)许可留置权、(b)出租人在租赁权益下的权利、(c)在资产负债表上具体指明的截至公司财务报表日期的留置权和(d)附表4.17所列的留置权以外的所有留置权。目标公司的资产(包括知识产权及合约权利)构成所有资产、权利及财产,而这些资产、权利及财产是用于经营目标公司现时进行及现时建议进行的业务,或由目标公司使用或持有,以供经营目标公司的业务,而这些资产、权利及财产合在一起,是足够及足以经营目标公司现时进行及现时建议进行的业务。
4.18雇员事项。
(a)目标公司不是任何集体谈判协议或其他合同的当事方,该协议或合同涵盖任何目标公司的任何雇员团体、劳工组织或任何目标公司的任何雇员的其他代表,而且公司不知道任何工会或其他方面为组织或代表这些雇员而进行的任何活动或程序。据公司所知,没有发生或受到任何罢工、怠工、纠察、停工或其他类似劳动活动的威胁。附表4.18(a)列出任何目标公司与受雇于目标公司或以独立承建商身份向目标公司提供服务的人之间所有尚未解决的劳工争议(包括尚未解决的申诉和年龄或其他歧视申诉)(如有的话)。任何目标公司的现任高级人员或雇员,均没有向任何目标公司提供书面通知,或据公司所知,提供口头通知,说明他或她计划终止与任何目标公司的雇佣关系。自2020年1月1日以来,没有发生任何影响目标公司员工的重大员工裁员、设施关闭或关闭(无论是自愿的还是法律或秩序规定的)、裁员、休假、临时裁员、重大工作时间表变更或工时、工资或工资减少,或其他影响目标公司员工的员工变动,或目前正在考虑、计划或宣布,包括由于新冠疫情或任何新冠疫情措施。自2020年1月1日以来,没有任何目标公司实施任何关闭工厂或员工裁员,这将触发《WARN法》规定的通知义务。
(b)每一目标公司(i)在所有重大方面均遵守并一直遵守关于雇用和雇用惯例、雇用条款和条件、健康和安全以及工资和工时的所有适用法律,以及关于歧视、残疾、劳动关系、工作时间、支付工资和加班工资、薪酬公平、移民、工人补偿、工作条件、雇员日程安排、职业安全和健康、家庭和医疗假以及雇员解雇的其他法律,并且没有收到书面通知,或据公司所知,口头通知,有任何涉及针对目标公司的不公平劳动做法的待决诉讼,(ii)不对任何重大的逾期拖欠工资或因未能遵守上述任何规定而受到的任何重大处罚负责,以及(iii)不对就雇员、独立承建商或顾问的失业补偿福利、社会保障或其他福利或义务向任何政府当局支付任何重大款项负责(在正常业务过程中按惯例支付的常规款项除外)。任何申请人、任何现任或前任雇员、任何声称是现任或前任雇员的人或任何政府当局,或声称违反任何明示或默示的雇佣合同、非法终止雇佣关系,或声称与雇佣关系有关的任何其他歧视性、不法或侵权行为,并无任何待决诉讼或据公司所知对目标公司提出威胁诉讼。
(c)本协议附表4.18(c)列出截至本协议日期的目标公司所有雇员的完整及准确名单,列出截至本协议日期的每名雇员(i)该雇员的姓名、职务或类别、雇主、地点、薪金水平(包括任何奖金、佣金、递延补偿或其他应付薪酬(目标公司可酌情决定支付的任何该等安排除外)),(ii)在截至2021年12月31日的财政年度支付的薪金以外的任何奖金、佣金或其他薪酬,以及(iii)任何工资、薪金、奖金,在截至2022年12月31日的财政年度内或在截至2022年12月31日的财政年度内应付给每位员工的佣金或其他补偿。除附表4.18(c)所述外,(A)任何雇员均不是与目标公司订立书面雇佣合约的一方,而每名雇员均是“随意”受雇的,及(B)目标公司已向其所有雇员足额支付应支付予雇员的所有工资、薪金、佣金、奖金及其他补偿,包括加班费补偿,而目标公司并无根据任何书面或据公司所知的口头协议或承诺或任何适用法律、惯例的条款,就向任何该等雇员支付遣散费而承担任何义务或责任(不论是否有条件),贸易或实践。在交易结束时或之前,目标公司的每一名雇员都将订立一份标准的雇员保密、发明和
A-19
与目标公司签订的限制性契约协议(无论是根据单独的协议,还是作为该雇员的整体雇佣协议的一部分),其形式和内容应为买方合理接受。
(d)附表4.18(d)载有任何目标公司目前聘用的所有独立订约人(包括顾问)的名单,以及每名独立订约人的职位、聘用该等人的实体、留用日期和薪酬率、最近的薪酬增加(或减少)及其数额。除附表4.18(d)所列的情况外,所有该等独立承建商均为与目标公司订立书面合约的一方。除附表4.18(d)所列情况外,每名该等独立承建商均与目标公司订立有关保密、不邀约及转让该等人的协议中的发明及版权的习惯契约,而该协议的副本已由公司提供予买方。就包括《守则》在内的适用法律而言,目前或在过去六(6)年内受聘于目标公司的所有独立承包商都是真正的独立承包商,而不是目标公司的雇员。每一独立承包商可在不到三十(30)天的通知后终止,任何目标公司没有义务支付遣散费或终止费。
4.19福利计划。
(a)附表4.19(a)载列的是目标公司每项福利计划(每一项为“公司福利计划”)的真实完整清单。就每个公司福利计划而言,没有任何未缴款或未适当应计的已供资福利债务,也没有任何未按准备金入账或未按照公认会计原则在公司财务中适当加注脚注的未供资福利债务。就《守则》第414(b)、(c)、(m)或(o)条而言,目标公司并不是或过去曾是“受控集团”的成员,亦无任何目标公司对任何就计划进行的集体议价承担任何法律责任,不论是否受ERISA的规定所规限。任何目标公司并无就任何公司福利计划向任何人作出任何书面或口头陈述,而该计划在任何重要方面均不符合公司福利计划。
(b)每份公司福利计划在所有重要方面,包括ERISA和守则,均一直遵照所有适用的法律运作。每一份公司福利计划,如果按照《守则》(i)第401(a)条的定义,拟为“合格”,则在其通过至本协议签署之日的期间内,已由IRS确定为合格(或基于已收到赞成意见函的原型计划),并且(ii)其相关信托已根据《守则》第501(a)条被确定为免税,或者目标公司已要求IRS在适用法律允许的期间内初步确定合格和/或豁免。不存在可能对此种公司福利计划的合格地位或此种信托的豁免地位产生不利影响的事实。
(c)就每一份涵盖目标公司任何现任或前任高级人员、董事、顾问或雇员(或其受益人)的公司福利计划而言,公司已向买方提供准确和完整的副本(如适用):(i)所有公司福利计划文本和协议及相关信托协议或年金合同(包括对其的任何修订、修改或补充);(ii)所有简要计划说明及其重大修改;(iii)三(3)最新表格5500(如适用)和年度报告,包括其所有附表;(iv)计划资产的最近年度和定期会计;(v)三(3)份最近的不歧视测试报告;(vi)从IRS收到的最近的确定信(如果有的话);(vii)最近的精算估值;(viii)与任何政府当局的所有重要通信。
(d)就每项公司福利计划而言:(i)该公司福利计划已按照其条款、《守则》和ERISA在所有重要方面进行管理和执行;(ii)没有发生违反信托责任的情况;(iii)没有任何诉讼待决,或据公司所知,没有任何威胁(除了对在正常管理过程中产生的福利的例行索偿);(iv)没有发生ERISA第406节或《守则》第4975节所界定的违禁交易,不包括依据法定或行政豁免而进行的交易;及(v)截止日期前到期的所有供款及保费已按ERISA的规定在所有重要方面作出,或已在公司财务的所有重要方面全面累积。
(e)任何公司福利计划都不是(i)“固定福利计划”(定义见守则第414(j)节),(ii)“多雇主计划”(定义见ERISA第3(37)节)或(iii)“多雇主计划”(如守则第413(c)节所述),或以其他方式受ERISA第四章或守则第412节的约束。任何目标公司或ERISA附属公司都没有根据ERISA第四章承担任何责任,或可能承担任何或有或其他责任,而且目前不存在预期会导致承担这种责任的任何条件。在截止日期后,任何公司福利计划都不会成为针对任何目标公司的多雇主计划。没有任何目标公司现时维持或曾经维持,或现时被要求或曾经被要求作出贡献或以其他方式作出贡献
A-20
参与《守则》第501(c)(9)条所界定的多雇主福利安排或自愿雇员受益人协会。
(f)在任何公司福利计划下,并无任何安排就任何雇员作出,而该等安排会导致目标公司因实施《守则》第280G或162(m)条而不能扣除的任何款额的支付,亦无任何安排根据该等安排,目标公司须就向该人支付的款项征收任何消费税,而须对该人作出“累算”或以其他方式补偿。
(g)对于属于“福利计划”的每个公司福利计划(如ERISA第3(1)节所述):(i)没有此种计划为目标公司的现任或前任雇员提供终止雇用后的医疗或死亡福利(法律规定的保险除外,该保险仅由这些雇员支付);(ii)没有任何此种计划下的准备金、资产、盈余或预付保费。每个目标公司都遵守了ERISA第601条及以下条款和守则第4980B条的规定。
(h)本协定和附属文件所设想的交易的完成将不会:(一)使任何个人有权获得遣散费、失业补偿金或其他福利或补偿;(二)加快支付或归属的时间,或增加任何个人应得或与之有关的任何补偿的数额;或(三)导致或满足支付补偿的条件,该条件与任何其他付款相结合,将导致《守则》第280G条所指的“超额降落伞付款”。目标公司并无就根据《守则》第43章征收的任何税款承担任何法律责任,亦无就ERISA第502(i)或(l)条所订的民事法律责任承担任何法律责任。
(i)除《守则》第4980B条或类似的州法律所要求的范围外,任何目标公司都不向任何前雇员或退休雇员提供健康或福利福利,或在任何在职雇员退休或以其他方式终止雇用或服务后有义务向该雇员提供此类福利。
(j)所有公司福利计划均可在截止日期当日或之后的任何时间终止,而不会导致买方或目标公司或其各自的附属公司因任何额外供款、罚款、保费、费用、罚款、消费税或任何其他费用或负债而承担任何法律责任。
(k)截至截止日期受《守则》第409A条规限的每份公司福利计划(每份为“第409A条计划”)均在附表4.19(k)中注明。本公司未发行或授予任何属于或受第409A条计划约束的公司期权或其他基于股权的奖励。每个第409A节计划的管理都符合《守则》第409A节的适用规定、根据该节制定的条例和根据该节发布的其他正式指导,并在文件上得到遵守。任何目标公司均不对任何雇员或其他服务提供者就任何可能根据守则第409A条须缴付任何税项的第409A条计划承担任何责任。根据任何第409A条计划支付的款项,均不受《守则》第409A(a)(1)条的惩罚所规限,或据公司所知,亦不会受该等惩罚所规限。没有任何合约或计划是任何目标公司的一方,也没有任何合约或计划是任何目标公司有义务就根据《守则》第409A条征收的任何税款或利息向任何雇员、顾问或董事作出补偿的。
4.20环境事项。除附表4.20所列的情况外:
(a)每一目标公司在所有重要方面均遵守并一直遵守所有适用的环境法,包括取得、保持良好的信誉,并在所有重要方面遵守环境法为其业务和经营所要求的所有许可证(“环境许可证”),没有任何行动有待处理,或据公司所知,没有任何行动威胁要撤销、修改或终止任何此种环境许可证,而且据公司所知,没有任何事实和情况,或目前存在的条件可能对持续遵守环境法和环境许可证产生不利影响,或需要资本支出来实现或保持持续遵守环境法和环境许可证。
(b)就任何(i)环境法、(ii)补救行动或(iii)释放或威胁释放危险材料而言,目标公司不是任何尚未执行的命令或与任何政府当局或其他人订立的合同的主体。任何目标公司都没有根据任何环境法承担任何责任或义务,无论是合同上的还是法律上的。
(c)没有对任何目标公司或目标公司的任何资产采取或正在采取或据公司所知威胁采取任何行动,声称目标公司可能严重违反任何环境法或环境许可证,或可能根据任何环境法承担任何重大责任。
A-21
(d)目标公司没有制造、处理、储存、处置、安排或允许处置、生成、处理或释放任何危险材料,也没有拥有或经营任何财产或设施,其方式已经或合理地预期会引起适用的环境法规定的任何物质责任或义务。据本公司所知,任何目标公司或目标公司目前或以前拥有、经营或租赁的任何财产,或目标公司为处置或处理危险材料而安排的任何财产,均不存在任何可合理预期会导致目标公司承担任何重大环境责任的事实、情况或条件。
(e)没有对目标公司的业务、经营或目前拥有、经营或租赁的财产进行调查,也没有对目标公司以前拥有、经营或租赁的财产进行调查,这些财产尚待调查,或据公司所知,有可能导致根据任何环境法或重大环境责任施加任何留置权的威胁。
(f)据公司所知,在目标公司的任何物业内并无任何(i)地下储存罐、(ii)含石棉物料或(iii)含多氯联苯的设备。
(g)公司已向买方提供对任何目标公司目前或以前拥有、租赁或经营的财产进行的所有与环境有关的场地评估、审计、研究、报告、分析和调查结果。
4.21与有关人士的交易。除附表4.21所列明的情况外,目标公司或其任何附属公司,或目标公司或其任何附属公司的任何高级人员、董事、经理、雇员、受托人或受益人,或上述任何事项的任何直系亲属(不论是直接或间接透过该人的任何附属公司)(上述每一项,均称为“有关人士”),目前或在过去三(3)年内,均为与目标公司进行的任何交易的一方,包括任何合约或其他安排(a),该等合约或安排规定由(高级人员除外)提供服务,目标公司的董事或雇员),(b)就不动产或个人财产的租金作出规定,或(c)以其他方式要求向任何关连人士或任何关连人士作为拥有人、高级人员、经理、董事而拥有权益的人(在符合以往惯例的正常业务过程中作为目标公司的董事、高级人员或雇员而提供的服务或开支除外,受托人或合伙人,或任何相关人士拥有任何直接或间接权益的人(持有的证券不超过上市公司未行使投票权或经济权益的百分之二(2%))。除附表4.21所列情况外,目标公司并无与任何关连人士订立任何尚未履行的合约或其他安排或承诺,亦无关连人士拥有任何在目标公司业务中使用的不动产或个人财产,或有形或无形(包括知识产权)的权利。目标公司的资产不包括来自关联人的任何应收款或其他债务,目标公司的负债不包括对关联人的任何应付款项或其他债务或承诺。
4.22保险。
(a)附表4.22(a)列出目标公司持有的与目标公司或其业务、财产、资产、董事、高级人员及雇员有关的所有保单(按保单号码、保险人、保险期间、保险金额、年度保费及保单种类),其副本已提供予买方。所有该等保险单下的所有应付及应付保费均已及时支付,而目标公司在其他方面实质上已遵守该等保险单的条款。每份保险单(一)是合法的、有效的、有约束力的、可强制执行的,并具有完全的效力和效力;(二)将继续具有法律效力、有约束力、可强制执行,并在结案后以相同的条款具有完全的效力和效力。目标公司没有任何自保或共保计划。在过去五(5)年内,目标公司并无接获任何保险承保人或代表任何保险承保人发出的任何通知,涉及或涉及任何不利的改变,或除在正常业务过程、保险条件、拒绝签发保单或不续期保单以外的任何改变。
(b)附表4.22(b)列出目标公司在过去五(5)年内提出的每项超过50000美元的个人保险索赔。每一目标公司均已向其保险人报告了合理预期会导致索赔的所有索赔和未决情况,除非未报告此种索赔对目标公司而言不具有重大的合理可能性。据本公司所知,没有发生任何事件,亦没有任何情况或情况会合理地预期(不论是否有通知或时间的流逝)会引起或作为拒绝任何该等保险索偿的依据。任何目标公司并没有就保险人拒绝承保的保险单提出任何索偿。
A-22
4.23簿册和记录。目标公司的所有财务账簿和记录在所有重大方面都是完整和准确的,并在所有重大方面均按照以往惯例和适用法律正常保存。
4.24医疗保健行业事项。
(a)自2018年1月1日以来,每个目标公司在所有重大方面均遵守所有适用的医疗保健法,包括(i)《联邦食品、药品和化妆品法》(“FDCA”);(ii)所有联邦或州刑事或民事欺诈和滥用法律(包括联邦反回扣法规(42 U.S.C. § 1320a-7(b))、《民事货币处罚法》(42 U.S.C. § 1320a-7(a))、《阳光法案》(42 U.S.C. § 1320a-7(h))、《排除法》(42 U.S.C. § 1320a-7)、《刑事虚假陈述法》(42 U.S.C. § 1320a-7b(a)、《斯塔克法》(42 U.S.C. § 1395nn)、《虚假索赔法》(31HIPAA(42 U.S.C. § § 1320d et seq.),以及任何类似的州或地方法律)和(iii)任何适用的州许可、披露和报告要求(所有上述规定,连同任何非美国司法管辖区的类似法律,包括联合王国,统称为“医疗保健法”)。没有目标公司收到FDA或任何其他类似监管机构关于任何待决行动的书面通知(包括任何“警告信”),声称任何目标公司的任何运营或活动严重违反任何适用的医疗保健法。在不限制上述一般性的情况下,每一目标公司目前和一直在实质上遵守与任何目标公司直接或间接制造、包装、标签、测试、分销、销售和/或营销任何药物或干细胞治疗人类疾病有关的所有医疗法律,包括与注册、调查使用、上市前批准、许可或申请批准、良好生产规范、良好实验室规范、良好临床规范、产品清单、配额、标签、广告、记录保存和报告归档有关的医疗法律。
(b)由任何目标公司进行或赞助的、打算提交给FDA或任何其他管理当局以支持监管批准的所有重要临床前和临床调查,在所有重要方面均符合由相关政府当局管理或发布的所有适用的保健法,包括(如适用的话)(i)《联邦法规》第21章第58部分所载的FDA关于进行非临床实验室研究的规定,(ii)FDA对设计、行为、性能、监测、审计、记录的适用要求,对《联邦法规》第21章第50、54、56和312部分所载临床试验的分析和报告,以及(iii)限制使用和披露个人可识别健康信息(包括HIPAA)的适用联邦、州和非美国医疗法律。
(c)每个目标公司要求向FDA或任何其他监管机构提交、维护或提供的所有重要报告、文件、索赔、许可证和通知均已如此提交、维护或提供。所有这些报告、文件、索赔、许可证和通知在提交之日在所有重要方面都是完整和准确的(或在随后提交的文件中得到更正或补充)。任何目标公司,或据公司所知,任何目标公司的任何高级职员、雇员或代理人,均未(i)向FDA或任何其他监管当局作出关于重要事实的不实陈述或任何欺诈性陈述,(ii)未披露要求向FDA或任何其他监管当局披露的重要事实,或(iii)在披露时作出行为、作出声明或未作出声明,合理预期将为FDA或任何其他监管机构提供一个合理的依据,使其能够援引其在《美联储第56号决议》中提出的“欺诈、不真实的事实陈述、贿赂和非法酬金”政策。Reg. 46 191(1991年9月10日)或任何类似的政策。任何目标公司,或据本公司所知,任何目标公司的任何高级职员、雇员或代理人,均未被裁定犯有任何罪行或从事任何行为,而21 U.S.C. § 335a(a)或任何类似的《保健法》或21 U.S.C. § 335a(b)或任何类似的《保健法》授权禁止该行为。任何目标公司,或据公司所知,任何目标公司的任何高级职员、雇员或代理人均未被判定犯有任何罪行或从事任何行为,而根据1935年《社会保障法》第1128条或任何医疗保健法,这些人可能被排除在联邦医疗保健计划之外。自本协议签订之日起,任何目标公司或公司所知的任何高级职员、雇员、承包商、供应商(以他们的身份)或代表任何目标公司进行研究或工作的其他实体或个人,均未受到任何可能导致实质性取消资格或排除在外的合理预期行动的待决或威胁。任何目标公司都不是任何公司诚信协议、监督协议、同意令、和解令或与任何政府当局签订或由任何政府当局强加的类似协议的当事方。
(d)目标公司没有收到来自FDA或任何其他管理当局或任何机构审查委员会的任何书面通知、信函或其他信函,要求终止、中止或实质性修改任何目标公司或其代表正在进行或计划进行的任何临床试验。
A-23
(e)自本协定签订之日起,任何目标公司就其产品生成的数据都不会受到任何政府当局就这些数据的真实性或科学完整性采取的有待采取或据公司所知受到威胁的任何书面管制行动的影响。
(f)据本公司所知,任何目标公司制造或分销的产品均未(i)在21 U.S.C. § 351(或任何类似的保健法)的含义内掺假,或(ii)在21 U.S.C. § 352(或任何类似的保健法)的含义内贴错商标。自2018年1月1日以来,任何目标公司或据公司所知,其各自的合同制造商均未收到来自FDA或任何其他监管机构的任何FDA表格483、警告信、无标题信函或其他类似信函或书面通知,指控或声称这些信函或书面通知严重违反了FDA或任何其他监管机构颁发给公司的任何适用的医疗法律或许可。自2018年1月1日以来,任何目标公司或据公司所知,任何目标公司的任何合同制造商所拥有的生产场所都没有或一直没有受到FDA或其他监管机构实施的关闭或进出口禁令的约束。
4.25某些商业惯例。
(a)目标公司或其各自代表没有(i)将任何资金用于与政治活动有关的非法捐款、礼物、娱乐或其他非法开支,(ii)向外国或国内政府官员或雇员、外国或国内政党或竞选活动非法付款,或违反经修订的1977年《美国反海外腐败法》或任何其他当地或外国反腐败或贿赂法的任何规定,或(iii)作出任何其他非法付款。目标公司或其各自的代表均未直接或间接向任何客户、供应商、政府雇员或其他有能力或可能有能力帮助或阻碍任何目标公司或协助任何目标公司进行任何实际或拟议的交易的人提供或同意给予任何非法礼物或任何重大金额的类似利益。
(b)每一目标公司的业务在任何时候都遵守所有适用法域的洗钱法规、根据这些法规制定的规则和条例以及任何政府当局颁布、管理或执行的任何相关或类似的规则、条例或准则,而且据公司所知,没有任何涉及目标公司的行动尚未完成或受到威胁。
(c)目标公司或其各自的任何董事或高级职员,或据公司所知,代表目标公司行事的任何其他代表目前未被列入特别指定的国民或其他被封锁者名单,或目前受到OFAC实施的任何美国制裁的其他人员,且目标公司在过去五(5)个财政年度内没有直接或间接使用任何资金,或向任何子公司、合资伙伴或其他人出借、出资或以其他方式提供此类资金,与在古巴、伊朗、叙利亚的任何销售或业务有关,苏丹、缅甸、俄罗斯或受外国资产管制处制裁的任何其他国家,或为资助目前受美国制裁或以其他方式违反外国资产管制处制裁的任何人的活动。
4.26投资公司法。任何目标公司都不是《投资公司法》所指的“投资公司”,即由“投资公司”直接或间接“控制”或代表“投资公司”行事的人,或被要求注册为“投资公司”的人。
4.27发现者和经纪人。除附表4.27所列的情况外,目标公司并无就与本条例所设想的交易有关的任何经纪、查询或其他费用或佣金而招致或将招致任何法律责任。
4.28独立调查。本公司对买方的业务、经营结果、前景、状况(财务或其他方面)或资产进行了独立的调查、审查和分析,并承认已为此目的向本公司提供了充分的查阅买方的人员、财产、资产、房地、簿册和记录以及其他文件和数据的渠道。本公司承认并同意:(a)在作出订立本协议和完成本协议所设想的交易的决定时,本公司完全依赖其本身的调查以及本协议(包括买方披露附表的有关部分)和根据本协议交付本公司的任何证书所载的买方的明确陈述和保证;及(b)买方或其任何代表均未就买方或本协议作出任何陈述或保证,除非本协议(包括买方披露附表的有关部分)或依据本协议向本公司交付的任何证书中明文规定。
4.29提供资料。本公司所提供或将提供的任何资料,均未明示列入或以提述方式纳入,最终亦未以提述方式列入或纳入:(a)任何有关表格8-K的现行报告,以及任何
A-24
就本协议或任何附属文件所设想的交易向任何政府当局或证券交易所提交的证物或任何其他报告、表格、登记或其他备案;(b)登记声明;或(c)就本协议所设想的交易的完成或(a)至(c)所指明的任何文件的任何修订而向买方股东和/或潜在投资者邮寄或以其他方式分发的证物,在提交、提供、邮寄或分发时(视情况而定),载有对重要事实的任何不实陈述,或忽略陈述根据作出这些陈述的情况而须在其中陈述或作出这些陈述所必需的任何重要事实,而不具误导性。本公司所提供或将提供的任何资料,在提交或分发(如适用的话)时,均不会包含任何有关重要事实的不实陈述,或略去陈述任何根据作出该等陈述的情况而须在该等陈述中陈述或作出该等陈述所必需的重要事实,而该等资料并无误导。尽管有上述规定,本公司并不就买方或其附属公司提供或代表买方或其附属公司提供的任何资料作出任何陈述、保证或契约。
4.30披露。公司在本协议(经公司披露附表修订)或附属文件中的任何陈述或保证,(a)不包含或将包含任何关于重要事实的不真实陈述,或(b)在与本协议、公司披露附表及附属文件所载的所有资料一并阅读时,不包含或将不包含任何必要的事实,以使其中所载的陈述或事实不具有重大误导性。
4.31无其他申述。除本公司在本条第四款(经公司披露附表修订)或附属文件中明示作出的陈述及保证外,本公司或代表本公司的任何其他人均不就任何目标公司或其各自的业务、经营、资产或负债,或本协议或任何其他附属文件所设想的交易作出任何明示或默示的陈述或保证,本公司在此明确否认任何其他陈述或保证,不论是否由本公司或其任何代表默示或作出。除公司在本条第四款(经公司披露附表修订)或附属文件中明示作出的陈述及保证外,本公司在此明确声明对向买方或其任何代表作出、传达或提供(口头或书面形式)的任何陈述、保证、预测、预测、陈述或资料(包括公司的任何代表已经或可能向买方或其任何代表提供的任何意见、资料、预测或意见)概不承担任何法律责任及责任,包括有关目标公司业务的可能成功或盈利能力的任何陈述或保证。
第五条
卖方代表和认股权证
除《公司披露附表》(其编号与本协议所指的《公司披露附表》)中的规定外,每一卖方在此分别(而非共同)向买方声明和保证,自本协议之日起(或就加入卖方而言,自该人成为加入卖方之日起),并于交易结束时如下:
5.1组织和地位。这种卖方,如果不是个人,则是一个按照其成立法域的法律有适当组织、有效存在和良好信誉的实体,拥有一切必要的权力和权力,拥有、租赁和经营其财产,并按目前的方式经营其业务。
5.2授权;具有约束力的协议。该卖方拥有一切必要的权力、权力和法律权利及能力,以执行和交付本协议及其作为当事方的每一份附属文件,履行该卖方在本协议项下和本协议项下的义务,并完成本协议及本协议所设想的交易。本协议以及卖方作为或被要求作为一方的每一份附属文件在交付时已经或应当由卖方正式有效地签署和交付,并假定本协议及任何该等附属文件得到其他各方的适当授权、签署和交付,即构成或在交付时应构成该卖方的法律、有效和具有约束力的义务,可根据其条款对该卖方强制执行,但可执行性例外情况除外。
5.3所有权。该卖方拥有附件一所列卖方名称对面所购股份的良好、有效和可销售的所有权,不存在任何和所有留置权(适用的证券法或公司组织文件规定的留置权除外)。除本协议外,该卖方购买的任何股份的表决或转让均不存在任何代理人、表决权、股东协议或其他协议或谅解,而该卖方是该卖方的一方或受该卖方约束。在截止日期将该卖方购买的股份交付买方时
A-25
根据本协议,该等所购股份的全部法律和实益权益,以及该等所购股份的良好、有效和可销售的所有权,不附带任何留置权(适用的证券法规定的留置权或买方招致的留置权除外),将转移给买方。
5.4政府批准。在该卖方执行、交付或履行本协议或任何附属文件的过程中,或在该卖方完成本协议或本协议所设想的交易时,无须取得或取得任何政府当局的同意,(a)本协议明确规定的备案,(b)根据反垄断法,(c)就交易向纽约证券交易所或其他国家交易所或美国证券交易委员会要求的备案,(d)《证券法》、《交易法》的任何适用要求,和/或任何国家的“蓝天”证券法及其下的规则和条例,以及(e)如果未能获得或作出此类同意或作出此类备案或通知,将不会合理地预期会严重损害或延迟该卖方完成交易的能力。
5.5不违反。由该卖方签立和交付本协议及其作为一方或受其他约束的每一份附属文件,并由该卖方完成本协议及其所设想的交易,以及该卖方遵守本协议及其任何条款,将不会:(a)如果该卖方是一个实体,与该卖方组织文件的任何规定相冲突或违反,(b)与该卖方或其任何财产或资产适用的任何法律、命令或同意相冲突或违反,或(c)(i)违反,(ii)构成违约(或因通知或时间流逝而构成违约的事件,或两者兼而有之);(iii)导致终止、撤回、暂停、取消或修改;(iv)加速该卖方根据以下规定要求的履行;(v)导致终止或加速履行;(vi)导致根据以下规定支付款项或提供补偿的义务;(vii)导致对该卖方的任何财产或资产产生任何留置权,(viii)引起取得任何第三方同意或向任何人提供任何通知的任何义务,或(ix)给予任何人宣布违约、行使任何补救、要求回扣、退款、罚款或更改交货时间表、加速到期或履行、取消、终止或修改任何权利、利益、义务或其他条款,根据任何条款、条件或规定,任何该卖方为一方或该卖方或其财产或资产受其他约束的合同,但任何偏离上述(a)条的情况除外,(b)或(c)没有且不会合理地预期会严重损害或延迟该卖方完成交易的能力。
5.6无诉讼。在任何政府当局面前或在任何政府当局面前,不存在针对或涉及该卖方的诉讼未决或据该卖方所知受到威胁的诉讼,也不存在任何尚未执行的命令,这将合理地预期会对该卖方完成本协议及其附属文件所设想的交易并履行其义务的能力产生重大和不利的影响,而该卖方是或必须是该协议及其附属文件的一方。
5.7投资陈述。该卖方:(a)是《证券法》条例D第501条(a)款所界定的“认可投资者”;(b)仅为投资目的,而不是为了转售或分销此种交易所股份而为自己购买其部分交易所股份;(c)已获悉并理解,交易所股份(i)是依据《证券法》和任何适用的州证券法的登记要求的一项或多项豁免而发行的,(二)没有也不应根据《证券法》或任何适用的州证券法进行登记,因此必须无限期持有,并且不得转售,除非这些交易所股票是根据《证券法》和所有适用的州证券法进行登记的,除非可获得登记豁免,并且(iii)根据该卖方锁定协议(如适用)对转让施加额外限制;(d)知道对买方的投资是一种投机性投资,可能面临完全损失的风险;(e)承认除登记权协议规定的情况外,买方没有义务根据《证券法》登记交易所股票。该卖方并无与任何人订立任何合约,以出售、转让或授予该人或任何第三人有关交易所股份的参与权。由于该卖方的商业或金融经验,或由于该卖方的“买方代表”的商业或金融经验(该术语在《证券法》第501(h)条中定义),该卖方能够评估在买方投资的风险和优点,并保护其与此投资有关的利益。该卖方已仔细阅读和理解买方或其代表向该卖方或该卖方代表提供的与在买方的投资有关的所有材料,并在该卖方认为可取的情况下,就本合同所设想的投资及其对该卖方的适宜性与其自己的律师、会计师或投资顾问进行了磋商。该卖方承认,交易所股票可能因不受该卖方控制的事件而被稀释。该卖方已完成其独立调查,并在确定本协议和本协议所设想的交易的法律、税务、财务和其他后果以及本协议和本协议所设想的交易是否适合该卖方及其特定情况时,充分依赖其自己的法律顾问、会计师、财务和其他代表的意见,并且除本协议所述情况外,未依赖买方或其代表的任何陈述或意见。此种卖方承认并同意,除第三条(包括有关的
A-26
买方披露附表的某些部分),买方或其任何代表均未作出任何陈述或保证,且该卖方并未得到任何人的保证或保证,(i)任何特定金额或在买方分配任何现金、财产或其他权益的事件,或(ii)交易所股份的盈利能力或价值以任何方式。该卖方:(A)由独立律师代理(或有机会咨询独立律师,但拒绝这样做);(B)有充分的权利和机会咨询该卖方的律师和其他顾问,并利用这一权利和机会;(C)仔细阅读并充分理解本协议全文,并由该律师向其充分解释;(D)充分了解本协议的内容和含义,本协议的意图和法律效力;(E)有权执行本协议,并在不受胁迫、胁迫或不当影响的情况下执行本协议。
5.8发现者和经纪人。任何经纪人、发现者或投资银行家均无权根据买方、目标公司或其任何关联公司根据卖方或其代表作出的安排,就本协议所设想的交易收取任何经纪、发现者或其他费用或佣金。
5.9提供的资料。该卖方所提供或将提供的任何资料,均未明示列入或以提述方式纳入,最终亦未以提述方式列入或纳入:(a)任何以表格8-K或表格6-K形式提交的当前报告及其任何证物或任何其他报告、表格,就本协议或任何附属文件所设想的交易向任何政府机构(包括证券交易委员会)进行的登记或其他备案;(b)登记声明;或(c)就本协议所设想的交易的完成或(a)至(c)所指明的任何文件的任何修订向买方股东和/或潜在投资者进行的邮寄或其他分发,在提交、提供、邮寄或分发时(视情况而定),载有对重要事实的任何不实陈述,或忽略陈述根据作出这些陈述的情况而须在其中陈述或为作出这些陈述而必须陈述的任何重要事实,而不具误导性。该卖方所提供或将提供的任何资料,在提交或分发(如适用的话)时,均不会包含任何关于重要事实的不实陈述,或略去陈述任何根据作出这些陈述的情况而需要在其中陈述或作出这些陈述所必需的重要事实,而不是误导。尽管有上述规定,该卖方并不就买方或其附属公司提供或代表买方或其附属公司提供的任何资料作出任何陈述、保证或契约。
5.10独立调查。该卖方已对买方的业务、经营结果、状况(财务或其他方面)或资产进行了独立调查、审查和分析,并承认已为此目的向其提供了充分的查阅买方的人员、财产、资产、房地、簿册和记录以及其他文件和数据的途径。该卖方承认并同意:(a)在作出订立本协议和完成本协议所设想的交易的决定时,它完全依赖于自己的调查以及本协议(包括买方披露附表的相关部分)和根据本协议交付给该卖方的任何证书中所载的买方的明确陈述和保证,(b)买方或其代表均未就买方或本协议作出任何陈述或保证,除非在本协议(包括买方披露附表的相关部分)或根据本协议交付给该卖方的任何证书中有明确规定。
5.11无其他申述。除该卖方在本第五条(经公司披露附表修订)或附属文件中明示作出的陈述和保证外,该卖方或代表其的任何其他人均不对该卖方或其业务、经营、资产或负债,或本协议或任何其他附属文件所设想的交易作出任何明示或默示的陈述或保证,该卖方在此明确否认任何其他陈述或保证,无论是否由该卖方或其任何代表默示或作出。
第六条
盟约
6.1获取和信息。
(a)在本协议日期起至本协议根据第8.1节终止或终止之日(“过渡期”)之前的期间内,在符合第6.13节的规定下,本公司应在正常营业时间内的合理时间,并应安排其代表在合理的时间间隔和通知下,向买方及其代表提供所有办公室和其他设施以及所有雇员、财产、合同、协议、承诺、账簿和记录、财务和运营数据及其他信息(包括
A-27
买方或其代表就目标公司及其各自的业务、资产、负债、财务状况、前景、经营、管理、雇员和其他方面(包括未经审计的季度财务报表,包括合并季度资产负债表和损益表、根据适用的证券法的要求向政府当局提交或收到的每份重要报告、附表和其他文件的副本,及独立公共会计师的工作底稿(须经该等会计师的同意或任何其他条件(如有)),并促使公司的每名代表合理地配合买方及其代表进行调查;但条件是买方及其代表进行任何该等活动的方式,不得不合理地干扰目标公司的业务或运作。
(b)在过渡期内,除第6.13条另有规定外,买方应在正常营业时间内的合理时间,在合理的间隔时间和通知下,给予并安排其代表合理地进入买方或其子公司的所有办公室和其他设施,以及所有雇员、财产、合同、协议、承诺、账簿和记录、财务和运营数据及其他信息(包括纳税申报表、内部工作文件、客户档案、客户合同和董事服务协议),或与买方或其子公司有关的信息(如公司或其代表就买方提出的合理要求),其子公司及其各自的业务、资产、负债、财务状况、前景、经营、管理、雇员和其他方面(包括未经审计的季度财务报表,包括合并的季度资产负债表和损益表,根据适用的证券法的要求向政府当局提交或收到的每份重要报告、附表和其他文件的副本,以及独立的公共会计师的工作底稿(如果需要得到这些会计师的同意或任何其他条件),并促使每一买方代表合理地配合公司及其代表进行调查;但前提是,本公司及其代表进行任何该等活动的方式,不得无理干扰买方或其任何附属公司的业务或经营。
6.2公司和卖方的业务行为。
(a)未经买方事先书面同意(此种同意不得被无理拒绝、附加条件或延迟),在过渡期内,除本协议或附属文件明文规定、适用法律(包括新冠疫情措施)要求或附表6.2规定的情况外,公司须并须安排其附属公司在符合以往惯例的正常经营过程中,(i)在所有重要方面经营各自的业务,(ii)遵守适用于目标公司及其各自的业务、资产和雇员的所有法律,及(iii)采取一切必要或适当的商业上合理的措施,在所有重要方面保持其各自的业务组织完整,保持其各自的经理、董事、高级人员、雇员及顾问的服务,并保持其各自的重要资产的管有、控制及状况,所有这些均符合以往的惯例。
(b)在不限制第6.2(a)条的一般性的情况下,除本协定或附属文件的条款所设想的、适用的法律(包括新冠疫情措施)所要求的或附表6.2所规定的情况外,在过渡期间,未经买方事先书面同意(此种同意不得被无理拒绝、附加条件或延迟),公司不得并应安排其子公司不:
(i)在任何方面修订、放弃或以其他方式更改其组织文件,但适用法律所规定的除外;
(ii)授权发行、发行、授予、出售、质押、处置或建议发行、授予、出售、质押或处置其任何股本证券或任何期权、认股权证、承诺、认购或任何种类的权利,以收购或出售其任何股本证券或其他证券,包括任何可转换为或可交换为其任何股份或任何类别的其他股本证券或证券的证券及任何其他基于股本的奖励,或就该等证券与第三人进行任何对冲交易;
(iii)分拆、合并、资本重组或重新分类其任何股份或其他股本权益,或就该等股份或其他股本权益发行任何其他证券,或就其股本权益支付或搁置任何股息或其他分配(不论是以现金、股本或财产或其任何组合),或直接或间接赎回、购买或以其他方式收购或要约收购其任何证券;
A-28
(iv)招致、创设、承担、预付或以其他方式承担(直接、或有或以其他方式)超过个别或合计50万美元的任何债务,向任何第三方提供贷款或垫款或投资(在正常经营过程中向雇员垫付费用除外),或担保或背书任何人的任何债务、负债或义务(个别或合计超过20万美元或50万美元);
(v)按照以往的惯例,增加雇员的工资、薪金或补偿,但不包括在正常业务过程中,但在任何情况下,增加的总额不得超过百分之五(5%),或作出或承诺向任何雇员支付任何奖金(不论是以现金、财产或证券支付),或实质上增加雇员的其他一般利益,或与任何现任顾问、高级人员、经理董事或雇员订立、订立、实质上修订或终止任何公司福利计划,但适用法律所规定的情况除外,依据任何公司福利计划的条款或在符合以往惯例的正常业务过程中;
(vi)作出或撤销任何与税务有关的重大选择,解决任何与税务有关的申索、诉讼、诉讼、诉讼、法律程序、仲裁、调查、审计或争议,提交任何经修订的报税表或退款申索,或对其会计或税务政策或程序作出任何重大更改,但适用法律或符合公认会计原则的规定除外;
(vii)向任何人转让或许可,或以其他方式延展、实质上修订或修改、准许失效或未能保存任何重要的公司注册知识产权、公司许可知识产权或其他公司知识产权(不包括在符合以往惯例的正常业务过程中向目标公司客户提供公司知识产权的非排他性许可),或向任何未订立保密协议的人披露任何商业秘密;
(viii)终止、放弃或转让任何公司物料合约下的任何重要权利,或订立任何将属公司物料合约的合约(在任何情况下均属符合以往惯例的正常业务过程以外);
(ix)在符合以往惯例的正常业务过程中,没有在所有重要方面备存其簿册、帐目及纪录;
(x)设立任何附属公司或订立任何新的业务范围;
(十一)没有作出商业上合理的努力,使有效的保险单或为其资产、业务和活动提供保险范围的更换或修订保险单的数额和范围,与现行有效的保险单和保险单的数额和范围大致相仿;
(xii)重估其任何重要资产,或对会计方法、原则或惯例作出任何重大更改,但须符合公认会计原则,并在谘询公司的外部核数师后作出更改;
(xiii)放弃、解除、转让、和解或妥协任何申索、诉讼或程序(包括与本协议或本协议所设想的交易有关的任何诉讼、诉讼、申索、程序或调查),但仅涉及支付(个别或合计)不超过$ 200,000的金钱损害赔偿(而非对目标公司或其附属公司施加衡平法上的救济或承认其不法行为)的放弃、解除、转让、和解或妥协除外,或以其他方式支付、解除或履行任何诉讼、责任或义务,除非该等金额已在公司财务报表中预留;
(xiv)关闭或实质上减少其任何设施的活动,或实施任何裁员或其他人员裁减或变动;
(十五)以合并、合并、取得股本权益或资产或任何其他形式的业务合并等方式,取得任何法团、合伙企业、有限责任公司、其他商业组织或其任何分立,或在符合以往惯例的正常经营过程之外取得任何重大数额的资产;
(十六)资本支出超过200000美元(单独用于任何项目(或一组相关项目)或总额超过500000美元);
(十七)采用全部或者部分清算、解散、合并、合并、重组、资本重组或者其他重组的方案;
A-29
(十八)自愿承担任何负债或债务(不论是绝对负债、应计负债、或有负债或其他负债),个别超过200000美元或合计超过500000美元,但依据公司重大合同或公司福利计划的条款除外;
(十九)出售、租赁、许可、转让、交换或互换、抵押或以其他方式质押或担保(包括证券化),或以其他方式处分其财产、资产或权利的任何重要部分;
(xx)就公司股本证券的表决订立任何协议、谅解或安排;
(xxi)采取任何可合理地预期会显著延迟或损害取得任何政府当局就本协定而须取得的同意的行动;
(xxii)加速收取任何贸易应收款项或延迟支付贸易应付款项或任何其他负债,但在符合以往惯例的正常业务过程中除外;
(xxiii)与任何关连人士订立、修订、放弃或终止任何交易(按照其条款终止的交易除外)(补偿及利益及预支开支除外,在每宗交易中,均是在符合以往惯例的正常业务过程中提供的);或
(xxiv)授权或同意进行上述任何行动。
(c)在不限制第6.2(a)及6.2(b)条的情况下,在过渡期内,未经买方事先书面同意,(i)公司不得发行任何公司证券,及(ii)在第(i)及(ii)条的任何情况下,卖方均不得出售、转让或处置该卖方拥有的任何公司证券,除非该公司证券(A)的接收人或受让人根据本协议签署并交付买方而成为加入卖方,Pubco和本公司卖方联合(在登记声明生效日期后,除非该受让人是公司内幕人士,而卖方联合载有该公司普通股股东确认其已收到与本协议所设想的交易有关的登记声明说明书),卖方联合以书面形式接受,并由买方、本公司和代表各方签署和交付,及(B)签立并向买方及本公司交付任何附属文件,而该附属文件如该受让人在本协议日期为签署卖方,或如该受让人在其他情况下须为签署卖方,则该受让人须为一方或受约束。双方应对附件一和每个卖方的按比例份额和按比例收益份额作出任何适当调整,以计入任何此类新的加入卖方。
6.3买方的业务行为。
(a)除非公司另有书面同意(此种同意不得被无理拒绝、附加条件或延迟),否则在过渡期内,除非本协议或附属文件(或任何交易融资所设想的)明确规定,适用法律(包括新冠疫情措施)或附表6.3所规定的,买方须(并须安排其附属公司)在符合以往惯例的正常经营过程中,(i)在所有重要方面经营其各自的业务,(ii)遵守适用于买方及其附属公司及其各自业务的所有法律,资产和雇员,以及(iii)采取一切必要或适当的商业上合理的措施,在所有重大方面保持其各自的业务组织完整,保持其各自的经理、董事、高级职员、雇员和顾问的服务,并保持其各自重大资产的拥有、控制和状况,所有这些都符合以往的惯例。尽管本协议第6.3节另有相反规定,本协议不得禁止或限制买方根据《买方组织文件》和《首次公开发行说明书》延长其完成业务合并(“延期”)的截止日期,不论是根据买方现行组织文件行使自动延期权利,还是通过修订《买方组织文件》延长该截止日期,且无需任何其他缔约方的同意。
(b)在不限制第6.3(a)条的一般性的情况下,除本协定或附属文件的条款(或任何交易融资所设想的)、适用法律(包括新冠疫情措施)所要求的或附表6.3所规定的情况外,在过渡期间,未经公司事先书面同意(此种同意不得被无理拒绝、附加条件或延迟),买方不得并应安排其子公司不:
A-30
(i)在任何方面修订、放弃或以其他方式更改其组织文件,但适用法律所规定的除外;
(ii)授权发行、发行、授予、出售、质押、处置或建议发行、授予、出售、质押或处置其任何股本证券或任何期权、认股权证、承诺、认购或任何种类的权利,以收购或出售其任何股本证券或其他证券,包括任何可转换为或可交换为其任何股本证券或任何类别的其他担保权益的证券,以及任何其他基于股本的奖励,或就该等证券与第三人进行任何对冲交易;
(iii)分拆、合并、资本重组或重新分类其任何股份或其他股本权益,或就该等股份或其他股本权益发行任何其他证券,或就该等股份或其他股本权益支付或搁置任何股息或其他分配(不论是以现金、股本或财产或其任何组合),或直接或间接赎回、购买或以其他方式收购或要约收购该等任何证券;
(iv)招致、创设、承担、预付或以其他方式承担(直接、或有或其他方式)超过100,000美元或合计300,000美元的任何债务,向任何第三方提供贷款或垫款或投资于任何第三方,或担保或背书任何人的任何债务、责任或义务(但本第6.3(b)(iv)条不阻止买方借入必要的资金,以资助(A)其日常行政费用和开支,以及与完成买方及本协议所设想的其他交易(包括任何交易融资)有关的开支,在过渡期间额外负债总额不超过1000000美元,以及(B)延期所需的费用和开支(包括买方向信托账户支付的款项)(x)根据买方现行组织文件规定的自动延期权,或(y)激励公众股东在延期赎回中不赎回其所持买方A类普通股的股份,与修订买方组织文件以延长完成业务合并的最后期限有关)(这些费用,“延期费用”);
(v)作出或撤销任何与税务有关的重大选择,解决任何与税务有关的申索、诉讼、诉讼、诉讼、法律程序、仲裁、调查、审计或争议,提交任何经修订的报税表或退款申索,或对其会计或税务政策或程序作出任何重大更改,但适用法律或符合公认会计原则的规定除外;
(vi)以任何对买方不利的方式修订、放弃或以其他方式更改信托协议;
(vii)终止、放弃或转让任何买方物料合约下的任何物料权利;
(viii)在符合以往惯例的正常业务过程中,没有在所有重要方面备存其簿册、帐目及纪录;
(ix)设立任何附属公司或订立任何新的业务;
(x)没有作出商业上合理的努力,使就其资产、业务和活动提供保险的保险单或更换或修订的保险单保持有效,其保险的数额和范围与目前有效的保险单大致相同;
(xi)对其任何重要资产重新估值,或对会计方法、原则或做法作出任何重大改变,但遵守公认会计原则所需的范围除外,并在咨询买方的外部审计员之后;
(xii)放弃、解除、转让、和解或妥协任何索赔、诉讼或程序(包括与本协议或本协议所设想的交易有关的任何诉讼、诉讼、索赔、程序或调查),但仅涉及支付不超过(单独或合计)200,000美元的金钱损害赔偿金(而不涉及对买方或其附属公司施加衡平法上的救济或承认其不法行为)的放弃、解除、转让、和解或妥协除外,或以其他方式支付、解除或履行任何诉讼、责任或义务,除非该金额已在买方财务报表中保留;
A-31
(xiii)收购任何法团、合伙企业、有限责任公司、其他商业组织或其任何分立,包括以合并、合并、收购股本权益或资产,或任何其他形式的企业合并,或在正常经营过程以外的任何重大资产;
(xiv)就任何项目(或一组有关项目)作出个别超过20万美元的资本开支,或作出总额超过50万美元的资本开支(为免生疑问,不包括产生任何开支);
(十五)采取全部或者部分清算、解散、合并、合并、重组、资本重组或者其他重组的方案;
(xvi)自愿承担任何责任或义务(不论是绝对的、应计的、或有的或其他的),个别超过200000美元,或合计超过500000美元(不包括任何费用的发生),但在过渡期间,并非依据截至本协定日期已存在的合同的条款,或在正常经营过程中订立的合同的条款,或根据本条第6.3款的条款订立的合同的条款;
(十七)出售、租赁、许可、转让、交换或互换、抵押或以其他方式质押或担保(包括证券化),或以其他方式处分其财产、资产或权利的任何重要部分;
(xviii)就买方证券的表决订立任何协议、谅解或安排;
(xix)采取任何可合理地预期会显著延迟或损害取得任何政府当局就本协定而须取得的同意的行动;或
(xx)授权或同意作出上述任何行动。
6.4公司财务报表。
(a)公司应在合理可行的情况下尽快(但在任何情况下不得迟于本协议日期后十(10)天)向买方交付目标公司2022财政年度的经审计综合财务报表(包括任何相关附注),包括目标公司截至2022年12月31日的经审计综合资产负债表,以及相关的经审计综合损益表、股东权益变动表和该财政年度的现金流量表,并由PCAOB的合格审计师根据公认会计原则和PCAOB标准进行审计(“2022年公司财务”)。公司应安排2022年公司财务报表(A)在所示期间按照一致适用的公认会计原则编制(附注中可能特别指出的除外),(B)按照PCAOB的标准进行审计,并载有公司审计师的报告,(C)在所有重大方面遵守适用的会计要求以及证券交易委员会、《交易法》和《证券法》自交付之日起生效的规则和条例(包括S-X条例或S-K条例),视情况而定)。
(b)在过渡期内,在每个历月、每个三个月季度和每个财政年度结束后的三十(30)个历日内,公司应向买方提交一份目标公司自最近资产负债表日期至该历月、季度或财政年度结束期间以及上一个财政年度适用的比较期间的未经审计的综合损益表和未经审计的综合资产负债表,在每一种情况下,均附有公司首席财务官的证明,说明所有这些财务报表均按照公认会计原则,公允地反映目标公司在所示日期或期间的合并财务状况和经营业绩,但须作年终审计调整,不包括脚注。本公司还将从本合同生效之日起至截止日期止,迅速向买方交付目标公司注册会计师可能出具的目标公司经审计的合并财务报表的副本。
6.5买方公开备案。在过渡期内,买方将及时向证券交易委员会提交其所有公开文件,并在所有重大方面遵守适用的证券法,并应在交易结束前利用其商业上合理的努力维持买方单位、买方A类普通股和买方公开认股权证在纽约证券交易所的上市;但前提是双方承认并同意,自交易结束后,双方只打算在适用的国家交易所上市买方A类普通股和买方公开认股权证。
A-32
6.6没有征求意见。
(a)就本协议而言,(i)“收购建议书”是指任何个人或团体在任何时间就替代交易提出的任何询问、建议或要约,或表示有意提出要约或提议的任何迹象,(ii)“替代交易”是指(A)就本公司、卖方、卖方代表及其各自的附属公司而言,一项交易(本协议所设想的交易除外),涉及出售(x)目标公司的全部或任何重要部分的业务或资产(在符合以往惯例的正常经营过程中除外)或(y)目标公司的任何股份或其他股本权益或利润,不论该交易采取的形式是出售股份或其他股本权益、资产、合并、合并、发行债务证券、管理合同、合资或合伙,(b)就买方及其附属公司而言,涉及买方的业务合并的交易(本协议所设想的交易除外)。
(b)在过渡期内,为促使其他缔约方继续承诺花费管理时间和财政资源来推进本协议所设想的交易,每一缔约方均不得(并应促使其代表)未经本公司和买方事先书面同意,直接或间接地(i)征求、协助、发起或协助任何收购建议书的提出、提交或宣布,或有意鼓励任何收购建议书,(ii)提供关于该缔约方或其关联企业(或关于任何卖方或卖方代表)的任何非公开信息,任何目标公司)或其各自的业务、营运、资产、负债、财务状况、前景或雇员与任何个人或团体(本协议的一方或其各自的代表除外)有关或响应收购建议书,(iii)参与或参与与任何个人或团体就收购建议书进行的讨论或谈判,或可能合理地预期会导致收购建议书的讨论或谈判,(iv)批准、背书或推荐任何收购建议书,或公开提议批准、背书或推荐任何收购建议书,(v)谈判或订立任何意向书,与任何收购建议书有关的原则协议、收购协议或其他类似协议,或(vi)免除任何第三方作为其当事方的任何保密协议的任何规定,或免除该第三方的任何规定。
(c)每一方应在切实可行的范围内尽快(无论如何应在48小时内)以书面形式通知其他方,该方或其任何代表(或就本公司、任何卖方或卖方代表而言)收到(i)关于或构成任何收购建议书的任何真诚查询、提议或要约、索取资料的请求或讨论或谈判的请求,或任何可能会产生收购建议书的真诚查询、提议或要约、索取资料的请求或讨论或谈判的请求,及(ii)就任何收购建议书而要求提供与该缔约方或其附属公司(或任何卖方或卖方代表、任何目标公司)有关的非公开资料,并在每宗个案中指明该等建议书的重要条款及条件(包括书面的副本或口头的书面摘要),以及作出该等查询、建议书、要约或要求提供资料的一方的身分。每一缔约方均应及时向其他缔约方通报任何此类查询、提议、要约或信息请求的情况。在过渡期内,每一缔约方应并应促使其代表立即停止并促使终止与任何人就任何收购建议书进行的任何邀约、讨论或谈判,并应并应指示其代表停止和终止任何此类邀约、讨论或谈判。
6.7禁止交易。本公司、卖方和卖方代表均承认并同意其知悉,且其各自的关联公司知悉(且其各自的代表知悉或在收到买方的任何重大非公开信息后将被告知)美国联邦证券法以及美国证券交易委员会和纽约证券交易所(或其他适用的国家交易所)根据这些法规颁布的规则和条例或其他法规(“联邦证券法”)以及其他适用的外国和国内法律对拥有上市公司重大非公开信息的人施加的限制。本公司、卖方代表和卖方在此同意,在其拥有此类重大非公开信息的同时,不得购买或出售买方的任何证券(根据第一条参与股票交易除外)、向任何第三方传达此类信息、违反此类法律对买方采取任何其他行动,或促使或鼓励任何第三方采取上述任何行为。
6.8某些事项的通知。在过渡期内,如果其他缔约方或其关联企业(或就本公司而言,任何卖方或卖方代表):(a)未能遵守或满足其或其关联企业应遵守或满足的任何契诺、条件或协议(或就本公司而言,(b)收到任何第三方(包括任何政府当局)的书面通知或其他通信,声称(i)就本协议所设想的交易需要或可能需要该第三方的同意,或(ii)该第三方或其不遵守任何法律
A-33
附属公司(或就本公司而言,任何卖方或卖方代表);(c)收到任何政府当局就本协议所设想的交易发出的任何通知或其他通讯;(d)发现任何事实或情况,或知悉任何事件的发生或不发生,而该等事件的发生或不发生,可合理地预期会导致或导致第七条所列的任何交割条件得不到满足,或该等条件的满足被实质上延迟;或(e)知悉以书面形式开始或威胁,任何针对该方或其任何关联公司(或就本公司而言,任何卖方或卖方代表)或其各自的任何财产或资产的诉讼,或据该方所知,该方或其关联公司(或就本公司而言,任何卖方或卖方代表)的任何高级职员、董事、合伙人、成员或经理以其或其身份就本协议所设想的交易的完成而采取的诉讼。任何此种通知均不构成提供通知的一方承认或承认本协议所载的任何陈述、保证或契约是否已被违反,而通知的一方是否已满足完成交易的任何条件。
6.9努力。
(a)在不违反本协定条款和条件的情况下,每一缔约方应利用其商业上合理的努力,并应与其他缔约方充分合作,采取或促使采取一切行动,并采取或促使采取一切根据适用的法律和条例合理必要、适当或可取的事情,以完成本协定所设想的交易(包括收到所有适用的政府当局同意书),并在实际可行的情况下尽快遵守适用于本协定所设想的交易的政府当局的所有要求。
(b)为促进而非限制第6.9(a)条,在旨在禁止、限制或管制具有垄断或限制贸易的目的或效果的行动的任何法律(“反托拉斯法”)所要求的范围内,本协议每一缔约方同意根据适用的反托拉斯法,就本协议所设想的交易,在切实可行的范围内尽快提出任何必要的备案或申请,费用由该缔约方自行承担,在合理可行的情况下,尽快提供根据反托拉斯法合理要求的任何补充资料和文件材料,并采取一切合理必要、适当或可取的其他行动,尽快导致反托拉斯法规定的适用等待期到期或终止,包括要求提前终止反托拉斯法规定的等待期。每一缔约方在根据任何反托拉斯法为本协定所设想的交易争取一切必要的批准和授权时,应利用其商业上合理的努力:(一)就任何提交或呈件以及任何调查或其他调查,包括由个人提起的任何诉讼,与对方或其附属机构在所有方面进行合作;(二)就该缔约方或其代表收到的或由该缔约方或其代表向其他缔约方发出的任何通信,向其他缔约方作出合理的通知,(iii)准许其他各方的代表及其各自的外部法律顾问在与任何政府当局举行的任何会议或会议之前,并在该政府当局或其他人允许的范围内,审查该政府当局向任何政府当局发出的任何通信,并相互协商,给予一名或多名其他缔约方代表出席和参加此类会议的机会;(iv)在禁止一名缔约方代表参加或出席任何会议或会议的情况下,其他缔约方应及时并合理地向该缔约方通报相关情况;(v)利用商业上合理的努力,合作提交任何备忘录、白皮书、文件、信函或其他书面通信,解释或为本协议所设想的交易辩护,阐明任何监管或竞争性论点,和/或回应任何政府当局提出的请求或反对。
(c)在本协定日期后,双方应在合理可行的情况下尽快相互合理合作,利用(并应促使其各自的附属机构利用)各自在商业上合理的努力,准备并向政府当局提出批准本协定所设想的交易的请求,并应尽一切商业上合理的努力,促使政府当局批准本协定所设想的交易。如果其他缔约方或其任何代表(或就本公司而言,任何卖方或卖方代表)收到这些政府当局就本协议所设想的交易发出的任何通知,每一缔约方应迅速向其他缔约方发出书面通知,并应迅速向其他缔约方提供该政府当局通知的副本。如任何政府当局要求举行听证会或会议,以便核准在此设想的交易,不论是在交易结束前还是在交易结束后,每一缔约方均应安排该缔约方的代表出席该听证会或会议。如根据任何适用法律对本协定所设想的交易提出反对,或任何适用的政府当局或任何个人提起(或威胁提起)任何诉讼,质疑本协定或任何附属文件所设想的任何交易违反任何适用法律,或以其他方式阻止在实质上
A-34
阻碍或实质上拖延本协议或由此设想的交易的完成,双方应利用其商业上合理的努力解决任何此种反对或行动,以便及时允许完成本协议和附属文件所设想的交易,包括为了解决此种反对或行动,而在任何情况下,如果不能解决,可以合理地预期这些反对或行动将阻止、实质上阻碍或实质上拖延本协议或由此设想的交易的完成。如果政府当局或个人对本协定或任何附属文件所设想的交易提出异议(或威胁提出异议),双方应并应促使其各自的代表相互合理合作,并利用各自在商业上合理的努力对任何此类行动提出异议和抵制,并撤销、取消、撤销或推翻任何现行有效的、禁止、阻止或限制完成本协定或附属文件所设想的交易的临时、初步或永久命令。
(d)在交易结束前,每一缔约方均应利用其商业上合理的努力,取得政府当局或其他第三人的任何必要同意,以便该缔约方或其附属机构完成本协定所设想的交易,或由于该缔约方或其附属机构执行、履行或完成本协定所设想的交易而需要的同意,而其他缔约方应就此种努力提供合理的合作。
6.10进一步保证。本协议双方应进一步相互合作,并利用各自在商业上合理的努力采取或促使采取一切行动,并采取或促使采取一切必要、适当或可取的行动,以便在合理可行的情况下尽快完成本协议所设想的交易,包括在可行的情况下尽快准备和提交所有文件,以执行所有必要的通知、报告和其他文件。
6.11登记声明。
(a)在本协议日期后,买方应在本公司的合理协助下,在切实可行的范围内尽快编制一份登记声明,并向证券交易委员会提交一份S-4表格(经不时修订或补充,包括其中所载的代理声明,即“登记声明”),说明根据《证券法》登记根据本协议将发行给加入卖方的买方A类普通股的股份,这些卖方首先执行并交付给买方,公司和代表各方在登记声明生效之日(作为签署卖方的受让人或在登记声明生效之日或之前作为加入卖方的另一加入卖方的受让人除外)之后的卖方参与人,且卖方参与人包含公司普通股股东的确认,他们已收到与本协议所设想的交易有关的登记声明招股说明书,该登记声明还将包含买方的代理声明(经修订,“代理声明”)的目的是为拟在买方特别会议上采取行动的事项向买方股东征集代理,并根据《买方组织文件》和《首次公开发行招股说明书》为公众股东提供一个机会,在股东就买方股东批准事项进行投票的同时赎回他们的买方A类普通股股份(“截止赎回”)。
(b)即使本协议另有相反规定,买方及本公司均同意,未经买方及本公司事先书面同意,本公司将不接受或同意由公司普通股股东(公司内幕人士除外)签立的日期在登记声明生效日期之前的卖方合并书,或不载有该公司普通股股东就本协议所设想的交易已收到登记声明招股章程的确认书的卖方合并书。
(c)代理声明应包括代理材料,以便在为此目的而召集和举行的买方股东特别大会(“买方特别会议”)上,向买方股东征集代理人,以投票赞成以下决议:(i)买方普通股股东按照买方组织文件,通过和批准本协议及在此设想或在此提及的交易,包括股票交易所(并在要求的范围内,发行与任何交易融资有关的任何股份),DCGL以及美国证券交易委员会和纽约证券交易所的规则和条例;(ii)采纳和批准经修订的买方组织文件中所载的经修订和重述的买方公司注册证书;(iii)采纳和批准新的股权激励计划,其形式由买方和公司共同商定,双方均合理行事(“激励计划”),该激励计划将规定对买方A类普通股的若干股份的奖励,这些股份相当于买方A类普通股股份总数的百分之十(10%)。
A-35
赎回);(iv)根据本协议第6.15条委任交割后买方委员会的成员;(v)本公司及买方日后须互相决定为进行股份交换及本协议所设想的其他交易而有需要或适当的其他事项(上述第(i)至(v)条所述的批准,统称为“买方股东批准事项”);(vi)修订买方经修订及重订的公司注册证书,于交割前生效,以取消第9.2(a)条所载的“赎回限制”规定,其中9.2(e)和9.2(f)与本协定所设想的交易有关(“赎回时效修正案”),以及(vii)在合理确定买方的情况下必要或适当时暂停买方特别会议。
(d)如在买方特别会议排定的日期,买方未收到代表足够股份数目的代理人,以取得所需的买方股东批准,不论是否达到法定人数,买方可连续一次或多次推迟或休会。关于注册声明,买方将根据适用法律和买方组织文件、DGCL以及SEC和纽约证券交易所或其他适用的国家交易所的规则和条例中规定的适用代理招标和注册声明规则,向SEC提交有关本协议所设想的交易的财务和其他信息。买方应予以配合,并为公司(及其法律顾问)提供一个合理的机会,在向SEC提交注册声明及其任何修订或补充之前,对该声明进行审查和评论,公司应向买方提供此类信息,这些信息涉及目标公司及其股东、高级职员、董事、雇员、资产、负债、状况(财务或其他方面)、业务和运营,这些信息可能需要或适合纳入注册声明或其任何修订或补充,该等资料由公司提供,须属真实及正确,而该等资料不得载有任何有关重要事实的不实陈述,或忽略陈述一项根据作出该等陈述的情况而作出该等陈述所需的重要事实,而该等陈述并无重大误导。
(e)买方应采取一切必要的合理和必要行动,以满足《证券法》、《交易法》和其他适用法律在登记声明、买方特别会议和截止赎回方面的要求。买方和本公司应并应促使其各子公司在合理的提前通知下,向本公司、买方和交割后的买方代表及其各自的代表提供各自的董事、高级管理人员和雇员,以便起草与本协议所设想的交易有关的公开文件,包括登记声明,并及时回应美国证交会的意见。各方应及时更正其提供的用于注册声明(及其他相关材料)的任何信息,如果此类信息在任何重要方面或适用法律的其他要求中被确定为虚假或误导性的,并在此范围内予以更正。买方应修订或补充《登记声明》,并安排将经修订或补充的《登记声明》提交证券交易委员会,并在适用法律要求的范围内,在符合本协议和买方组织文件的条款和条件的情况下,分发给买方股东。
(f)买方应在其他各方的协助下,迅速回应证券交易委员会对《注册声明》的任何评论,并应利用其商业上合理的努力,促使《注册声明》从证券交易委员会“清除”评论并生效。买方应向公司提供任何书面意见的副本,并应在收到买方或其代表从证券交易委员会或其工作人员收到的有关注册声明、买方特别会议和截止赎回的任何重要口头意见后立即通知公司,并应在此情况下给予公司一个合理的机会,以审查和评论对此类意见提出的任何书面或重要口头答复。
(g)在登记声明“清除”证交会的评论并生效后,买方应在切实可行的范围内尽快将登记声明分发给买方的股东,并根据该声明,在登记声明生效后三十(30)天内,按照DGCL的规定召集买方特别会议。
(h)买方在编制、归档和分发登记声明、根据登记声明征集代理人、召集和举行买方特别会议和截止赎回时,应遵守所有适用的法律、纽约证券交易所或将在其上上市的其他适用的国家交易所的任何适用的规则和条例、《买方组织文件》和本协议。
A-36
(i)如果买方股东在买方特别会议上批准赎回限制修正案,则在买方特别会议之后和截止日期之前,买方应立即按照赎回限制修正案所设想的修正案修订买方组织文件。
6.12公开公告。
(a)双方同意,在过渡期内,未经买方和公司事先书面同意(不得无理拒绝、附加条件或延迟同意),任何一方或其任何关联公司不得就本协议或附属文件或本协议或本协议或本协议所设想的交易(包括其存在或地位)发布、备案或公告,除非适用法律或任何证券交易所的规则或条例可能要求发布或公告,在这种情况下,适用方应迅速将此种义务通知买方和本公司(如适用),并应利用其商业上合理的努力,让买方和本公司(如适用)有合理的时间就此种发布或公告发表意见,并在此种发布或公告之前安排任何必要的备案。
(b)买方和本公司应相互商定,并在本协议执行后(但无论如何应在此后四(4)个工作日内)在切实可行的范围内尽快发布一份新闻稿,宣布本协议的执行(“签署新闻稿”)。在签署新闻稿发布后,买方应迅速提交一份表格8-K的当前报告(“签署文件”),连同签署新闻稿和联邦证券法要求的对本协议的描述,公司应在提交文件之前审查、评论和批准(该批准不得被无理拒绝、附加条件或延迟)(无论如何,公司应审查、评论和批准此种签署文件不迟于第三次(3rd)本协议执行后的营业日)。买方、本公司和代表各方应相互商定,并在交易结束后(但无论如何在交易结束后四(4)个工作日内)在切实可行的范围内尽快发布一份新闻稿,宣布本协议所设想的交易完成(“交易结束新闻稿”)。在结束新闻稿发布后,买方应立即以表格8-K提交一份当前报告(“结束文件”),并附上结束新闻稿和联邦证券法要求的结束说明,代表各方应在提交前审查、评论和批准(批准不得被无理拒绝、附加条件或延迟)。就签署新闻稿、签署文件、结束文件、结束新闻稿或由一方或代表一方就本协议所设想的交易向任何政府机构或其他第三方提出的任何其他报告、声明、提交通知或申请的编写而言,每一方均应应在任何其他方的要求下,向双方提供关于其本人、各自的董事、高级职员和股东的所有信息,以及与本协议所设想的交易或任何其他报告有关的合理必要或可取的其他事项,一缔约方或其代表就本协议所设想的交易向任何第三方和/或任何政府当局作出的陈述、备案、通知或申请。
6.13保密资料。
(a)本公司、卖方及卖方代表在此同意,在过渡期内,以及在本协议根据第八条终止的情况下,在终止后的两(2)年内,他们应并应促使各自的代表:(i)处理并严格保密任何买方机密信息,并且不会将其用于任何目的(除非与完成本协议或附属文件所设想的交易有关,履行其在本协议或本协议下的义务,执行其在本协议或本协议下的权利,或代表买方或其子公司履行其授权职责),未经买方事先书面同意,不得直接或间接披露、分发、发布、传播或以其他方式向任何第三方提供任何买方保密信息;以及(ii)如果公司、任何卖方、卖方代表或其各自的任何代表在过渡期内,或如果本协议根据第八条终止,在终止后的两(2)年内,在法律上被迫披露任何买方保密信息,(a)在法律许可的范围内,向买方迅速提供书面通知,通知该等规定,以便买方或其附属机构在未能取得该等保护令或其他补救或买方放弃遵守本条第6.13(a)及(B)条的情况下,可寻求保护令或其他补救或放弃遵守本条,费用由买方承担,只提供法律规定应由外部律师书面告知的买方保密信息部分,并作出商业上合理的努力,以保证将给予这种买方保密信息保密待遇。如本协议终止,而本协议所设想的交易未能完成,本公司及卖方代表应(并应促使其各自的代表)迅速向买方交付或销毁(由买方选择)任何及所有买方机密资料副本(以任何形式或媒介),并销毁所有
A-37
说明、备忘录、摘要、分析、汇编和与之有关或以之为基础的其他著述;但本公司、卖方和卖方代表及其各自的代表有权保存适用法律或真实记录保留政策所要求的任何记录;此外,任何未归还或销毁的买方机密信息仍应遵守本协议规定的保密义务。
(b)买方在此同意,在过渡期内,如果本协议按照第八条的规定终止,在终止后的两(2)年内,买方应(并应促使其代表):(i)严格保密地处理和持有任何公司机密信息,并且不会将其用于任何目的(除非与完成本协议或附属文件所设想的交易、履行其在本协议或本协议下的义务或执行其在本协议或本协议下的权利有关),也不会直接或间接披露、分发、发布,未经公司事先书面同意,向任何第三方传播或以其他方式提供任何公司机密信息;(ii)如买方或其任何代表在过渡期内,或如本协议根据第八条被终止,则在终止后的两(2)年内,在法律上被迫披露任何公司机密信息,(A)在法律允许的范围内,向公司迅速提供书面通知,说明此种要求,以便公司可自行寻求,如未能获得保护令或其他补救,或公司放弃遵守本条第6.13(b)及(B)条,则只提供该等公司机密资料中法律规定须由外部大律师以书面通知提供的部分,并作出商业上合理的努力,以取得保密处理将获给予该等公司机密资料的保证。如本协议终止,而本协议所设想的交易未能完成,则买方应(并应促使其代表)迅速向公司交付或销毁(由买方选择)公司机密信息的任何和所有副本(任何形式或媒介),并销毁与之有关或基于之的所有笔记、备忘录、摘要、分析、汇编和其他文字;但前提是买方及其代表有权保存适用法律要求的任何记录或真诚的记录保留政策;此外,任何未被退回或销毁的公司机密信息仍应遵守本协议规定的保密义务。尽管有上述规定,买方及其代表仍应被允许在联邦证券法要求的范围内披露任何和所有公司机密信息。
6.14文件和资料。在截止日期后,买方和本公司应并应安排其各自的子公司在第七(7第)截止日期的周年纪念日,保留截止日期存在的与目标公司业务有关的所有簿册、纪录及其他文件,并在公司及其附属公司的正常营业时间内(如适用的话)应合理要求和合理通知提供该等簿册、纪录及文件,以供买方代表查阅和复印。该等簿册、纪录或文件不得在第七次(7第)买方或其附属公司(包括任何目标公司)在截止日期的周年日,而没有事先以书面通知买方代表,也没有给予买方代表取得该等财产的合理机会。
6.15结束后董事会和执行干事。
(a)双方应采取一切必要行动,包括促使买方董事辞职,以便自交易结束时起,买方董事会(“交易结束后买方董事会”)将由七(7)人组成。交易结束后,双方应立即采取一切必要行动,指定并任命交易结束后买方董事会成员(这些人,即“董事”)(一)在交易结束前由买方指定的两(2)人,其中至少一人应符合适用的国家交易所规则规定的独立董事资格;(二)在交易结束前由公司指定的五(5)人,其中至少三(3)人应符合适用的国家交易所规则规定的独立董事资格;收盘后买方委员会将满足适用法律和适用的国家交易所上市规则所规定的所有多样性和其他要求。关闭后公司的董事会应与关闭后的采购人董事会相同。在交易结束时或之前,买方将向每位董事提供一份惯例董事赔偿协议,其形式和实质内容应为该董事合理接受,并在交易结束时生效(如果较晚,则为该董事的任命)。
(b)双方应采取一切必要行动,包括促使买方公司的执行人员辞职,以便在交易结束后立即分别担任买方公司首席执行官和首席财务官的个人与交易结束前担任买方公司首席执行官和首席财务官的个人相同(在同一职位上)(除非公司希望自行决定指定另一名合格人员担任该职位,在这种情况下,公司指定的其他人员应担任该职位)。
A-38
6.16董事及高级人员的赔偿;尾部保险。
(a)双方同意,买方或公司的现任或前任董事和高级人员,以及在买方或公司(“D & O受保人”)的要求下,作为另一公司、合伙企业、合资企业、信托、养老金或其他雇员福利计划或企业的董事、高级人员、成员、受托人或受托人的每一人(“D & O受保人”),根据其组织文件或任何D & O受保人与买方或公司之间的任何补偿、雇用或其他类似协议,有权获得开脱、补偿和垫付费用,在每一种情况下,如在本协议日期生效,应在协议结束后继续有效,并在适用法律允许的范围内按照各自的条款继续完全有效。在交易结束后的六(6)年期间内,买方和公司应促使买方和公司的组织文件在适用法律允许的范围内,就免除责任、赔偿和向D & O受弥偿人预支费用方面所载的条款,不低于本协议日期在适用的买方或公司组织文件中所载的条款。本条第6.16条的条文在截止日期后仍然有效,并旨在为每名D & O获弥偿人及其各自的继承人和代表的利益服务,并可由他们强制执行。
(b)为了买方及公司董事和高级人员的利益,买方应获准在交割前获得并全额支付一份“尾部”保险单的保险费,该保险单为交割前发生的事件提供自交割起至多六年期间的保险(“D & O尾部保险”),该保险单实质上相当于买方或公司的现有保险单,而且在任何情况下,在适用的情况下,其保险总额不低于(如无法获得实质上同等的保险)现有最佳保险。如买方和本公司获得D & O尾部保险,则买方和本公司应维持D & O尾部保险的全部效力和效力,并继续履行该保险项下的义务,买方和本公司应及时支付或安排支付与D & O尾部保险有关的所有保费。
6.17信托账户收益。双方同意,在交易结束时或交易结束后,信托账户中的资金在计入交易结束赎回的付款后,以及买方从任何交易融资中获得的任何收益,应首先用于支付(i)买方的应计费用,(ii)买方的首次公开发行递延费用(包括应付给首次公开发行承销商的现金金额和任何法律费用),(iii)买方欠保荐人的任何费用(包括递延费用)、其他行政费用和由买方或代表买方或延期费用产生的费用,(iv)买方在关闭时的任何其他负债及(v)公司的应计但未付的开支。这些费用以及必须通过交付买方证券支付的任何费用将在结算时支付。任何剩余现金将用于买方及其子公司(包括目标公司)的营运资金和一般公司用途。
6.18交易融资。在不限制本协议所载任何相反规定的情况下,在过渡期内,买方应根据买方与本公司约定的条款(该协议不得被无理拒绝、附加条件或延迟)真诚地寻求(但不应被要求)订立股权或债务融资协议(任何此类协议、“融资协议”以及此类融资协议所设想的融资、“交易融资”),并且,如果买方提出要求,(x)本公司应执行并交付此类融资协议,以及(y)本公司应并应促使其代表,与买方就此种融资协议进行合理合作(包括根据买方的合理要求,让公司的高级管理层参加任何投资者会议和路演)。此类融资协议可包括现有公众股东的非赎回协议,以及与任何投资者签订的担保协议和私募认购协议(无论是股权还是债务,以及此类私募是与买方还是公司)。除非公司和买方(如果买方不是融资协议的一方)根据融资协议的条款允许或以书面形式批准(该批准不得被无理拒绝、附加条件或延迟),以及下列任何不会实质上增加条件或对公司或买方施加任何新的重大义务的行为除外,在过渡期内,买方和本公司不得(i)减少买方或本公司根据任何附加融资协议应收取的承诺投资金额,或减少或损害买方或本公司在任何重大方面根据任何融资协议应享有的权利,或(ii)允许对任何融资协议的任何条款或补救措施作出任何修订或修改、放弃(全部或部分)或同意修改(包括同意终止),或在每种情况下对任何融资协议的任何条款或补救措施作出任何替换,(x)在任何重要方面,以及(y)不包括其中所设想的或由此而明示准许的任何转让或转让(而无须对该等转让或转让条文作出任何进一步的修订、修改或放弃)。买方和本公司应尽其商业上合理的努力,根据融资协议完成交易融资。
A-39
6.19就业协定。在交易结束前,公司应尽其合理的最大努力促使附表6.19所列的人在每一人与买方(或其附属公司)之间以公司和买方合理可接受的形式和实质订立自交易结束时起生效的雇佣协议(“雇佣协议”)。
6.20 GIOSTAR供应协议;公司业务重组。
(a)在交割前,本公司应并应促使其附属公司GIOSTAR Research Private Limited(“GS”)真诚地谈判本公司、买方和GS之间符合本合同附件二所列条款的供应协议(“GIOSTAR供应协议”),该协议的形式和内容自交割时起生效,其形式和内容应为买方合理接受。
(b)目标公司及卖方须在本协议日期后,在切实可行范围内尽快完成本协议附表6.20(b)所述的目标公司及目标公司及卖方各自附属公司的业务重组(“公司重组”)。
第七条
结案条件
7.1各缔约方义务的条件。每一方完成股票交换和本文所述其他交易的义务,须由公司和买方满足或书面放弃(在允许的情况下)以下条件:
(a)所需的买方股东批准。在买方特别会议上根据《代理声明》提交买方股东表决的买方股东批准事项,应经买方股东在买方特别会议上根据《买方组织文件》、适用法律和《代理声明》进行的必要表决通过(“所要求的买方股东批准”)。
(b)反托拉斯法。根据任何反托拉斯法适用于完成本协议的任何等待期(及其任何延期)均已届满或终止。
(c)必要的监管批准。为完成本协定所设想的交易,必须从任何政府当局取得或与任何政府当局作出的所有同意,均应已取得或作出。
(d)必要的同意。为完成附表7.1(d)所列的本协定所设想的交易而须向任何第三人(政府当局除外)取得或与任何第三人(政府当局除外)作出的同意,均须已取得或作出。
(e)没有不利的法律或命令。任何政府当局均不得颁布、发布、颁布、执行或订立当时有效的任何法律或命令(不论是临时、初步或永久的),其效力是使本协定所设想的交易或协议成为非法,或以其他方式阻止或禁止完成本协定所设想的交易。
(f)有形资产净值测试。如果买方股东在买方特别会议上未批准赎回限制修正案,则买方在交割前(在交割后赎回和任何交易融资生效后)或在交割后交易(包括交割后赎回和任何交易融资)合并有形资产净值至少为5000,001美元(根据《交易法》第3a51-1(g)(1)条规则计算和确定)。
(g)采购人组织文件。买方应以经修订的买方组织文件的基本形式对其组织文件进行修订和重述。
(h)任命为委员会成员。结束后采购人委员会的成员应在结束时按照第6.15节的要求选出或任命。
A-40
(i)国家交易所上市。买方在交易结束后和交易结束赎回、交易所股票的发行、任何交易融资和本协议所设想的任何其他交易生效后,应已收到买方和本公司合理接受的证据,证明买方A类普通股的股票在交易结束后应继续在纽约证券交易所上市或在另一国家交易所上市。
(j)登记声明。注册声明应已由证券交易委员会宣布生效,并应在交易结束时继续有效,任何停止令或类似命令均不对注册声明有效。
7.2公司和卖方义务的条件。除第7.1节所指明的条件外,本公司及卖方完成股份交换及本协议所设想的其他交易的义务,须符合或(由本公司)书面放弃下列条件:
(a)申述和担保。本协议及由买方或代表买方依据本协议交付的任何证明书所载的买方的所有陈述及保证,在本协议日期及截止日期均属真实及正确,犹如是在截止日期作出的一样,但(i)只涉及某一特定日期的事项的陈述及保证(而该等陈述及保证在该日期已属准确)除外,(ii)任何未能真实和正确地(但未对重要性或重大不利影响作出任何限定或限制)个别地或整体地没有对买方产生或对买方不会产生重大不利影响的情况,亦不会合理地预期会对买方产生重大不利影响。
(b)协定和盟约。买方应在所有重大方面履行买方的所有义务,并在所有重大方面遵守买方根据本协定应在截止日期当日或之前履行或遵守的所有协议和契约。
(c)没有买方材料的不利影响。自本协议持续和未予修正之日起,买方不应受到任何重大不利影响。
(d)某些辅助文件。卖方登记权协议自交易结束之日起将按照协议条款全面生效。
(e)结束交付。
(i)工作人员证书。买方须已向公司交付一份日期为截止日期的证明书,该证明书须由买方的执行人员以该身分签署,证明符合第7.2(a)、7.2(b)及7.2(c)条所指明的条件。
(二)秘书证书。买方须已向公司交付一份由其秘书或其他执行人员发出的证明书,证明并附上(A)自截止日期起生效的买方组织文件的副本,(B)授权和批准执行、交付和履行本协议及其作为当事方或受其约束的每一份附属文件的买方董事会决议,以及完成本协议及本协议所设想的交易,(C)已取得规定的买方股东批准的证据,以及(D)获授权执行本协议或任何附属文件的高级人员的任职情况,而买方是或须是该等文件的一方,或受其他方面的约束。
(三)良好的地位。买方应在截止日期前三十(30)天内,从买方组织管辖权的适当政府主管部门,以及在截止日期时买方有资格作为外国实体经营业务的彼此管辖部门,向公司交付一份合格的买方长期证书(或适用于这些管辖部门的类似文件),并在每一种情况下,只要这些管辖部门一般都有合格的长期证书或类似文件。
7.3买方义务的条件。除第7.1节规定的条件外,买方完成股票交易所和本协议所设想的其他交易的义务,须满足或书面放弃(由买方)下列条件:
(a)申述和担保。本协议及本公司或任何卖方依据本协议交付或代表本公司或任何卖方交付的任何证书所载本公司及卖方的所有陈述及保证均属真实
A-41
并在本协议日期当日及截止日期当日及截止日期当日更正,犹如在截止日期作出一样,但(i)那些只涉及某一特定日期的事项的申述及保证(而该等申述及保证在该日期即属准确),及(ii)任何未能真实及正确,而该等申述及保证(在不影响有关重要性或重大不利影响的任何限定或限制的情况下)个别或整体而言,并无亦不会合理地预期会对该等事项产生重大不利影响,或就目标公司整体或任何卖方而言。
(b)协定和盟约。本公司、卖方和卖方代表应在所有重大方面履行其各自的所有义务,并在所有重大方面遵守其在本协议下的所有协议和契约,由其在截止日期或之前履行或遵守。
(c)无实质性不利影响。自本协议持续且未得到修正之日起,目标公司作为一个整体不会发生任何重大不利影响。
(d)某些辅助文件。(一)未在本协议日期签署并交付锁定协议的各重要卖方应已正式签署并向买方交付锁定协议;(二)未在本协议日期签署并交付注册权协议的卖方应已正式签署并向买方交付注册权协议。每份《锁定协议》和《非竞争协议》及《卖方登记权协议》应根据协议的条款在交易结束时完全生效。
(e)公司重组。公司应在买方合理接受的形式和实质上完成公司重组。
(f)结束交付。
(i)工作人员证书。买方须已收到公司的证明书,日期为截止日期,由公司执行人员以该身分签署,证明符合第7.3(a)、7.3(b)及7.3(c)条所指明的条件。
(二)卖方证书。买方应已收到每个卖方出具的日期为截止日期的证书,该证书由该卖方签署,证明该卖方满足第7.3(a)和7.3(b)节规定的条件。
(三)秘书证书。公司须已向买方交付一份由公司秘书签立的证明书,证明(A)自截止日期(紧接截止日期前)起生效的公司组织文件的有效性及效力,并附上(B)公司董事会授权及批准执行、交付及履行本协议及公司须为或须为其一方或受其约束的每一份附属文件的必要决议,以及完成股票交易所及在此及由此而设想的其他交易,及(C)获授权执行本协议或任何附属文件的公司高级人员的在职情况,而该等文件是或须是公司的一方,或受其他方面的约束。
(四)良好的地位。在截止日期前三十(30)天内,公司应已向买方交付每一目标公司的良好常备证书(或适用于该等司法管辖区的类似文件),这些证书是由目标公司的组织管辖区的适当政府主管部门提供的,并由目标公司在截止日期时有资格作为外国公司或其他实体经营业务的彼此司法管辖区提供的,但在每一种情况下,只要这些司法管辖区一般都有良好的常备证书或类似文件。
(五)就业协定。买方应已收到附表6.19所列每一人之间的雇佣协议,其形式和内容均为买方和公司合理接受的,每一份该等雇佣协议均由该人妥为签立。
(六)GIOSTAR供应协议。买方应已收到《GIOSTAR供应协议》,其形式和内容应为买方合理接受,并符合附件二所列条款,并由本公司、GS和该协议的任何其他适用方正式签署。
A-42
(vii)公司可转换证券。买方应已收到买方合理接受的证据,证明截至收盘时,本公司已全部终止、终止和注销任何未清偿的公司可转换证券或其承诺,而不承担任何责任。
(八)股票证书和转让工具。如适用,买方应已从每一卖方收到代表所购股份的股票证书(或已妥为签立的遗失股票证书誓章,其形式和实质均为买方合理可接受的,并符合英格兰和威尔士法律),以及已签立的以买方(或其代名人)为受益人并在公司账簿上合理可接受的形式转让所购股份的转让文书。
(九)法律意见。买方应已收到本公司一名或多名律师就惯例公司事项向买方提交的一份正式签署的意见,其形式和实质均为买方合理满意的,日期为截止日期。
(x)某些合同的终止。买方应已收到买方合理接受的证据,证明附表7.3(f)(x)所列涉及目标公司和/或卖方或其他关联人的合同已终止,目标公司在此项下不再承担任何义务或责任。
7.4条件受挫。尽管本协议中有任何相反的规定,任何一方均不得依赖本第七条中所述的任何条件未能得到满足,如果这种不满足是由于该方或其关联公司(或就本公司、任何目标公司、卖方代表或任何卖方而言)未能遵守或履行其在本协议中所述的任何约定或义务所致。
第八条
终止和费用
8.1终止。本协议可以终止,本协议所设想的交易可以在交易结束前的任何时候放弃,具体情况如下:
(a)买方与公司的相互书面同意;
(b)如第七条所载的任何结束条件在2023年8月14日(即“结束日期”)前仍未获满足或放弃,则由买方或公司以书面通知作出(但如买方寻求并获得延期,超过买方目前完成2023年8月14日的业务合并的截止日期,则买方有权向公司提供书面通知,将结束日期延长一个或多个额外期间,合计最短可延长(i)三(3)个月,(ii)在买方依据该延期完成其业务合并的最后日期截止的期间(在买方可在该延期中取得的任何自动延期权生效后,而买方可在无须修订其组织文件的情况下延长其完成业务合并的截止日期)及(iii)买方所决定的期间;但如一方或其附属公司(或就本公司而言)违反或违反本协议,则该一方不得根据本条第8.1(b)条有权终止本协议,任何卖方或卖方代表)在本协议项下的任何陈述、保证、契约或义务是导致或导致未能在外部日期或之前完成交割的原因;
(c)如属主管司法管辖权的政府当局已发出命令或采取任何其他行动永久限制、禁止或以其他方式禁止本协议所设想的交易,而该命令或其他行动已成为最终的和不可上诉的,则由买方或公司发出书面通知,但如一方或其附属公司(或就本公司而言)未能根据本条终止本协议,则该一方无权依据本第8.1(c)条终止本协议,任何卖方或卖方代表)遵守本协议的任何规定是该政府当局采取此种行动的实质性原因或实质性结果;
(d)如(i)买方违反其在本协议内所载的任何陈述、保证、契诺或协议,或买方的任何陈述或保证在任何情况下变得不真实或不准确,而该等陈述或保证会导致第7.2(a)或7.2(b)条所列的条件不获满足(为本协议的日期或(如较后)该等违反的日期的目的而将截止日期视为),及(ii)该违反或不准确之处不能得到纠正,或不能在以下较早的时间内得到纠正
A-43
(A)在向买方提供有关违约或不准确之书面通知后二十(20)天,或(B)外部日期;但如果公司、任何卖方或卖方代表在该时间严重违反本协议,则公司无权依据本第8.1(d)条终止本协议;
(e)如(i)公司、任何卖方或卖方代表违反本协议所载的任何其陈述、保证、契诺或协议,或如该等各方的任何陈述或保证在任何情况下变得不真实或不准确,将会导致第7.3(a)或7.3(b)条所列的条件不获满足(为本协议的日期或(如较后)该等违反的日期的目的而将截止日期视为),及(ii)在向公司提供有关该等违约或不准确的书面通知后(A)二十(20)天内或在(B)以外日期后(以较早者为准),该等违约或不准确无法得到纠正或未能得到纠正;但如买方在该时间严重违反本协议而未得到纠正,则买方无权依据本条第8.1(e)条终止本协议;
(f)由买方向公司发出书面通知,如在本协议日期后对作为整体的目标公司有重大不利影响,而该影响是未予修正和持续的;或
(g)由买方或公司向另一方发出书面通知,如买方特别会议已举行(包括任何休会或延期)并已结束,买方的股东已妥为表决,而所需的买方股东批准并未获得。
8.2终止的效力。只有在第8.1节所述情况下,并根据适用缔约方向其他适用缔约方发出的书面通知,才可终止本协定,该书面通知规定了终止协定的依据,包括终止协定所依据的第8.1节的规定。如果本协议根据第8.1节有效终止,则本协议立即失效,任何一方或其各自的任何代表均不承担任何责任,每一方的所有权利和义务均应终止,但以下情况除外:(i)第6.12、6.13、8.3、9.1节、第十条和第8.2节在本协议终止后仍然有效,并且(ii)本协议中的任何内容均不免除任何一方因故意违反本协议项下的任何陈述、保证、约定或义务或针对该一方的任何欺诈索赔而承担的责任,在任何一种情况下,在本协定终止之前(在上述第(i)和(ii)款的每一种情况下,均须遵守第9.1节)。在不限制和不受上述规定限制的情况下,除第8.3节和第8.2节(但不受第9.1节的限制)另有权利根据第10.9节寻求强制令、具体履行或其他衡平法上的救济,在交易结束前,对于另一方违反本协定所载的任何陈述、保证、契约或其他协议,或对于本协定所设想的交易,双方在适用的情况下有权根据第8.1节终止本协定。
8.3费用和开支。除第1.3、6.17、9.1、10.16和10.17条另有规定外,与本协定和本协定所设想的交易有关的所有费用应由承担这些费用的一方支付。本协议中使用的“费用”应包括一缔约方或其代表为授权、准备、谈判、执行或履行本协议或与本协议有关的任何附属文件以及与完成本协议有关的所有其他事项而支付的所有自付费用(包括律师、会计师、投资银行家、财务顾问、融资来源、专家和顾问的所有费用和开支)。就买方而言,费用应包括企业合并完成后首次公开发行的任何和所有递延费用(包括应付给承销商的费用或佣金以及任何法律费用)和任何延期费用。尽管有上述规定,买方和本公司各自应承担任何适用的反垄断法规定的所有备案费用和开支的百分之五十(50%),包括与经修订的1976年《哈特-斯科特-罗迪诺反托拉斯改进法》所要求的任何合并前通知有关的费用和开支,以及与根据登记声明和/或代理声明提交证券或进行证券登记有关的费用和开支。
第九条
豁免和释放
9.1对信托债权的放弃。请参阅《首次公开发行股票招股说明书》。本公司、卖方及卖方代表均谨此声明并保证已阅读首次公开发行说明书,并理解买方已为买方的公众股东(包括买方的承销商获得的超额配售股份)(即“公众股东”)的利益设立了一个信托账户,其中包含首次公开发行的收益以及买方的承销商以及与首次公开发行同时进行的某些私募所获得的超额配售证券(包括不时产生的利息),除非首次公开发行说明书中另有说明,买方只能在下列情况下从信托账户支付款项:(a)如果公共股东选择赎回其在
A-44
与完成其初始业务合并(如首次公开发行招股说明书中使用的术语)(“业务合并”)有关,或与修订《买方组织文件》以延长买方完成业务合并的最后期限有关,(b)如果买方未能在首次公开发行结束后十五(15)个月内完成业务合并,则与公众股东有关,该合并已通过修订《买方组织文件》而延长至2023年8月14日,并可通过进一步修订《买方组织文件》而进一步延长,(c)就信托帐户所持有的款额所赚取的任何利息、缴付任何税项所需的款额及最多达$ 100,000的解散开支,或(d)在业务合并完成后或同时向买方支付。本公司、卖方及卖方代表均代表本公司及其附属公司同意,即使本协议有任何相反的规定,本公司、卖方或卖方代表或其各自的任何附属公司现在或以后任何时候都不享有任何权利、所有权,信托账户中任何款项的利息或任何种类的债权或信托账户的任何分配,或对信托账户提出任何债权(包括信托账户的任何分配),而不论此种债权是否因本协议或任何其他事项而产生、与本协议有关或以任何方式与本协议或任何其他事项有关,也不论此种债权是否基于合同、侵权行为、权益或任何其他法律责任理论而产生(统称为“解除债权”)。本公司、卖方及卖方代表各自及其附属公司在此不可撤销地放弃任何该等方或其任何附属公司现在或将来可能对信托账户(包括来自该账户的任何分配)提出的任何已解除的索赔,并且不会以任何理由(包括据称违反本协议或与买方或其附属公司的任何其他协议)向信托账户(包括来自该账户的任何分配)寻求追索。本公司、卖方和卖方代表均同意并承认,此种不可撤销的放弃对本协议具有重要意义,买方及其附属公司特别依赖此种放弃来促使买方加入本协议。本公司、卖方和卖方代表均进一步打算并理解此种放弃根据适用法律对该缔约方及其每一附属公司有效、具有约束力和可强制执行。只要本公司、卖方或卖方代表或其各自的任何附属公司根据与买方或其代表有关的任何事项、与之有关的事项或因之产生的事项而提起任何诉讼,而该诉讼程序寻求对买方或其代表、本公司每一方的全部或部分金钱救济,卖方和卖方代表在此承认并同意,其及其附属公司的唯一补救办法应是针对信托账户以外的资金,并且此种索赔不应允许该方或其任何附属公司(或任何代表他们或代替他们提出索赔的人)对信托账户提出任何索赔(包括来自该账户的任何分配)或其中所载的任何金额。如果公司、卖方或卖方代表或他们各自的任何关联公司根据与买方或其代表有关的任何事项或因任何事项而提起诉讼,而诉讼程序寻求对信托账户(包括由此产生的任何分配)或公众股东的全部或部分救济,无论是以金钱损害赔偿或强制性救济的形式,买方及其代表(如适用)有权向公司、卖方、卖方代表及其各自的关联公司(如适用)追偿,如果买方或其代表(视情况而定)在此种诉讼中胜诉,则与任何此种诉讼有关的相关法律费用和费用。本第9.1节应在本协议因任何理由终止后继续有效,并无限期地继续下去。
9.2释放和不起诉的盟约。自交割之日起,在适用法律允许的最大限度内,每一卖方(代表其本身及其拥有该卖方的任何股份或其他权益的关联公司)(“解除人”),特此解除和解除目标公司在法律上和权益上已知或未知的任何和所有行动、义务、协议、债务和责任,而该解除人现在拥有的任何和所有行动、义务、协议、债务和责任,在截止日期当日或之前,或由于截止日期当日或之前发生的任何事项或由该事项引起的任何事项,包括根据目标公司的组织文件、合同或其他规定,以及是否与截止日期当日或之后提出的索赔有关的任何权利,对目标公司曾经拥有或以后可能拥有对目标公司的任何权利,包括要求目标公司作出赔偿或补偿。自交易结束后及之后,每名解除关连人士在此不可撤销地承诺,避免直接或间接地针对目标公司或其各自的附属公司提出任何诉讼,或开始或安排展开任何种类的诉讼,而该等诉讼是基于任何拟在此发布的事项。尽管本协议另有相反规定,本协议所列的解除和限制不适用于解除人根据本协议或任何附属文件的条款和条件或附表9.2所列的任何其他事项对任何一方提出的任何索偿。
第十条
杂项
10.1生存。本协定或根据本协定由缔约方或其各自代表交付或代表交付的任何证书或文书中所载的缔约方的陈述和保证,不应在交易结束后继续有效,自交易结束后,缔约方及其各自代表不应再承担任何义务,也不应就此对缔约方或其各自代表提出任何索赔或提起诉讼。双方及其各自代表在本协定或任何证书或
A-45
根据本协议交付的文书,包括因违反该等契诺或协议而产生的任何权利,不应在交割后继续有效,但本协议及其中所载的根据其条款适用或将在交割后全部或部分履行的契诺和协议除外(该等契诺应在交割后继续有效,直至完全按照其条款履行为止)。
10.2无追索权。本协议只能针对被明确指定为缔约方的实体执行,而任何基于本协议或本协议所设想的交易或与本协议或本协议所设想的交易有关的索赔或诉讼理由只能针对本协议所规定的与该缔约方有关的具体义务。(a)任何一方的前任、现任或未来的董事、高级职员、雇员、保荐人、注册人、成员、合伙人、股东、关联人、代理人、律师、顾问或代表或关联人,以及(b)任何上述任何一方的前任、现任或未来的董事、高级职员、雇员、保荐人、注册人、成员、合伙人、股东、关联人、股东、关联人、股东、关联人、代理人、律师、顾问或代表或关联人,均不对任何一项或多项陈述、保证、契约承担任何责任(无论是在合同、侵权、股权或其他方面),任何一方或多方在本协议下的协议或其他义务或责任,或对基于本协议或本协议所设想的交易、产生于本协议或与本协议或本协议所设想的交易有关的任何索赔的要求。
10.3通知。本协议项下的所有通知、同意书、弃权书和其他通信均应以书面形式发出,并在以下情况下被视为已妥为发出:(i)当面送达;(ii)通过传真或其他电子方式(包括电子邮件)送达,并确认收到;(iii)在送达后一个工作日(如果是通过信誉良好的、国家认可的隔夜快递服务发送);(iv)在邮寄后三(3)个工作日(如果是通过挂号信或挂号信发送)、预付费和所要求的回执(在每种情况下)在以下地址(或在类似通知所指明的缔约方的其他地址):
如在交割时或交割前向买方:
Apeiron Capital Investment Corp. |
连同一份副本(该副本不构成通知)以:
Ellenoff Grossman & Schole LLP |
如致采购人代表,致:
Apeiron Capital赞助有限责任公司 |
连同一份副本(该副本不构成通知)以:
Ellenoff Grossman & Schole LLP |
如对本公司,则对:
GIO世界健康有限公司。 |
连同一份副本(该副本不构成通知)以:
Winston & Strawn LLP |
A-46
如果向卖方代表:
德文·帕特尔 |
连同一份副本(该副本不构成通知)以:
Winston & Strawn LLP |
如向任何卖方,则向:
(i)就签署卖方而言,在签署页上该签署卖方的签署下方所列的该签署卖方的地址,或
(ii)就任何加入卖方而言,适用的卖方加入书所载该加入卖方的地址。 |
连同一份副本(该副本不构成通知)以:
Winston & Strawn LLP
和
卖方代表 |
如果在交易结束后交给买方,则交给:
GIO世界健康控股有限公司。
和
买方代表 |
连同一份副本(该副本不构成通知)以:
Winston & Strawn LLP
和
Ellenoff Grossman & Schole LLP |
10.4约束力;转让。本协议及本协议的所有条款对本协议双方及其各自的继承人和被许可的受让人具有约束力,并对其有利。未经买方和本公司(在交割后,买方代表和卖方代表)事先书面同意,本协议不得依法转让或以其他方式转让,任何未经此种同意的转让均为无效;但此种转让不得解除转让方在本协议下的义务。
10.5第三方。除第6.16节规定的D & O受保人的权利和第10.18节规定的EGS、保证人和W & S的权利外,双方均承认并同意为本协议的明确第三方受益人。
A-47
为施行该等条文及有关的强制执行条文,本协议或任何一方就本协议所设想的交易而签立的任何文书或文件所载的任何内容,均不得对任何并非本协议或本协议或本协议的任何一方的当事人或该当事人的继承者或准许的受让者,在其身上产生任何权利,亦不得当作是为其利益而签立任何权利。
10.6仲裁。因本协定或本协定所设想的交易(“争议”)而产生、与之有关或与之有关的任何和所有争议、争议和索赔(临时限制令、初步强制令、永久强制令或其他衡平法救济的申请或根据本条第10.6款要求强制执行某项决议的申请除外,以及任何将由独立专家根据第1.3节裁定的争议)均应受本条第10.6款管辖。首先,一方当事人必须就任何争端向受此种争端影响的其他当事方提供书面通知,该通知必须对受此种争端影响的事项作出合理详细的说明。此种争端所涉各方应设法在受此种争端影响的其他各方收到此种争端的通知之日起十(10)个工作日内(即“解决期限”),以友好方式解决争端;但如果在此种争端发生后六十(60)天内没有作出裁决,任何争端本来可以合理地预期会成为没有实际意义的或在其他方面不相关的争端,则此种争端不应有解决期限。在解决期间未解决的任何争议可立即提交仲裁,并可根据当时存在的《商事仲裁规则》(AAA程序)(“AAA程序”)以仲裁方式最终解决。此种争端的任何当事方均可将争端提交给AAA,以便在解决期限之后启动程序。如果AAA程序和本协议有冲突,则由本协议的条款控制。仲裁应由AAA指定的一名仲裁员在争议提交给AAA后立即(但无论如何应在五(5)个工作日内)进行,该仲裁员应为每一受争议当事方合理接受的仲裁员,该仲裁员应为具有根据购置协议仲裁争议的丰富经验的商业律师。仲裁员应接受其任命,并在其提名并被争议各方接受后立即(但无论如何应在五(5)个工作日内)开始仲裁程序。程序应精简和高效。仲裁员应根据特拉华州的实体法对争议作出裁决。时间至关重要。受争议的每一方当事人应在确认仲裁员的任命后二十(20)天内向仲裁员提出解决争议的建议。仲裁员有权命令任何一方当事人作出或不作出与本协议、附属文件和适用法律相一致的任何事情,包括履行其合同义务;但仲裁员应限于根据上述权力命令(并为免生疑问,应命令)有关一方当事人(或适用的一方当事人)只遵守其中一项或另一项建议书。仲裁员的裁决应采用书面形式,并应包括对仲裁员选择一项或另一项建议的理由的合理解释。仲裁地应在纽约州。仲裁的语文应为英文。
10.7管辖法律;管辖权。本协议应受特拉华州法律的管辖、解释和执行,而不考虑其中的法律冲突原则。除第1.3和10.6节另有规定外,因本协定而产生或与本协定有关的一切诉讼,均应仅在纽约、纽约的任何州或联邦法院(或其任何上诉法院)(“指定法院”)审理和裁定。除第1.3和10.6节另有规定外,本协议每一方在此(a)就本协议任何一方提出的因本协议而产生或与本协议有关的任何诉讼而言,服从任何指定法院的专属管辖权,(b)不可撤销地放弃,并同意在任何此类诉讼中不以动议、抗辩或其他方式主张其本人不受上述法院的管辖、其财产被豁免或免于扣押或执行、诉讼是在不方便的法院提出的任何主张,诉讼地点不适当,或本协议或本协议所设想的交易不得在任何指定法院或由任何指定法院强制执行。每一当事方同意,任何诉讼的最后判决应是结论性的,并可通过对判决提起诉讼或以法律规定的任何其他方式在其他法域予以执行。每一缔约方均不可撤销地同意以其本人或其财产的名义,在与本协定所设想的交易有关的任何其他诉讼中,以第10.3节规定的适用地址向该缔约方送达传票和申诉以及任何其他程序。本条第10.7款的任何规定均不影响任何一方以法律允许的任何其他方式为法律程序服务的权利。
10.8放弃审判。在此,每一方在适用法律允许的最大限度内,对因本协议或本协议所设想的交易而直接或间接引起的任何诉讼,或与本协议或本协议或本协议或本协议所设想的交易有关的任何诉讼,放弃其可能拥有的由陪审团进行审判的任何权利。本协议(A)中的每一方均证明,任何其他方的代表均未明确或以其他方式表示,在任何行动的情况下,该其他方不会寻求强制执行上述放弃;(B)确认,除其他外,本协议中的每一方均已通过相互放弃和证明的方式达成本协议
A-48
10.9具体业绩。每一缔约方均承认,每一缔约方完成本协议所设想的交易的权利是独一无二的,承认并申明,如果任何缔约方违反本协议,金钱损害赔偿可能不足,而未违反本协议的缔约方在法律上可能没有充分的补救办法,并同意,如果本协议的任何条款不是由适用缔约方按照其具体条款履行或以其他方式被违反,则将发生无法弥补的损害。因此,每一方均有权寻求强制令或限制令,以防止违反本协议,并寻求具体执行本协议的条款和规定,而无需提供任何保证金或其他担保,或证明金钱损失将是不充分的,这是对该方根据本协议在法律上或公平上可能有权享有的任何其他权利或补救的补充。
10.10可分割性。如果本协议中的任何条款在某一法域被认定为无效、非法或不可执行,则应仅在使该协议有效、合法和可执行所必需的范围内,就所涉法域对该条款进行修改或删除,而本协议其余条款的有效性、合法性和可执行性不应因此而受到任何影响或损害,也不应因此而影响该条款在任何其他法域的有效性、合法性或可执行性。一旦确定任何条款或其他条款无效、非法或无法执行,双方将以适当和公平的条款取代任何无效、非法或无法执行的条款,该条款在可能有效、合法和可执行的范围内执行这种无效、非法或无法执行的条款的意图和目的。
10.11修正案。本协议只能通过签署由买方、本公司、买方代表和卖方代表签署的书面文书予以修订、补充或修改;但未经卖方事先书面同意,任何修订、补充或修改不得对卖方造成与其他卖方不相称的重大不利影响。
10.12放弃。买方及本公司各自代表其本身及其附属公司,以及卖方代表代表其本身及卖方,均可全权酌情决定(a)延长任何其他非关联方履行任何义务或其他行为的时间,(b)放弃本协议或根据本协议交付的任何文件所载该等其他非关联方的陈述和保证中的任何不准确之处,以及(c)放弃该等其他非关联方遵守本协议所载的任何契诺或条件。任何此类延期或放弃只有在一方或多方签署的书面文书(包括在本协议规定的范围内由买方代表或卖方代表代替该缔约方)中规定的情况下才有效。尽管有上述规定,任何一方在行使本协议项下的任何权利方面的任何失败或拖延,均不应被视为放弃,也不应因任何一次或部分行使本协议项下的任何其他权利而排除任何其他或进一步的行使。尽管有上述规定,买方在交割后对本协议任何条款的任何放弃也应事先征得买方代表的书面同意。
10.13全面协定。本协议及本协议提及的文件或文书,包括本协议所附的任何附件、证物和附表,其附件、证物和附表以引用方式并入本协议,连同附属文件,体现了本协议各方对本协议所载主题事项的全部协议和谅解。除本协议或本协议提及的文件或文书以外,本协议不存在任何限制、承诺、陈述、保证、约定或承诺,这些限制、承诺、承诺、陈述、保证、约定或承诺统统取代各方之前就本协议所载主题事项达成的所有协议和谅解。
10.14口译。本协定所载的目录及条款和章节标题仅供参考,不属于双方协定的一部分,不应以任何方式影响本协定的含义或解释。在本协议中,除非上下文另有要求:(a)所使用的任何代词应包括相应的男性、女性或中性形式,单数的词语,包括任何定义的术语,包括复数,反之亦然;(b)提及任何人包括该人的继承人和受让人,但在适用的情况下,只有在本协议允许这些继承人和受让人的情况下,(c)本协议或任何附属文件中使用但未另作定义的任何会计术语具有根据公认会计原则赋予该术语的含义;(d)“包括”(并具有相关含义的“包括”)是指在不限制该术语之前或之后的任何描述的一般性的情况下,在每种情况下应被视为后面加上“但不限于”等字;(e)“本协议”、“本协议”等字,在每一种情况下,“hereby”和其他具有类似意义的词语应被视为是指整个本协议,而不是指本协议的任何特定部分或其他细分;(f)在每一种情况下,在本协议中使用的“if”和其他具有类似意义的词语应被视为后面是“且仅当”;(g)“或”一词是指“和/或”;(h)在每一种情况下,凡提及“普通过程”或“普通业务过程”一词,均应被视为后面是“符合以往惯例”;(i)任何协议、文书,本文或本文提及的任何协议或文书中定义或提及的保险单、法律或命令,是指不时修订、修改或补充的协议、文书、保险单、法律或命令,包括(在协议或文书的情况下)通过放弃或同意,以及(在法规、条例、规则或命令的情况下)通过继承类似的继承法规、条例、规则或命令
A-49
(j)除另有说明外,本协定中所有提及的“部分”、“条款”、“附表”、“附件”和“附件”等词语均指本协定的各部分、条款、附表、附件和附件;(k)“美元”或“美元”是指美元。本协议中对个人董事的任何提述应包括该个人的理事机构的任何成员,而本协议中对个人高级职员的任何提述应包括为该个人担任基本类似职位的任何人。本协议或任何附属文件中对个人股东或股东的任何提述,均应包括以任何形式持有该个人股权的任何适用的所有人,包括就买方而言,根据DGCL或其组织文件对其股东的提述。双方共同参与了本协定的谈判和起草工作。因此,如果出现模棱两可或意图或解释问题,本协议应被解释为由双方共同起草,不得因本协议任何条款的作者身份而产生有利于或不利于任何一方的推定或举证责任。如任何合约、文件、证明书或文书由本公司代表并保证由本公司给予、交付、提供或提供,以使该等合约、文件、证明书或文书被视为已给予、交付、提供并提供予买方或其代表,则该等合约、文书或文书,证书或仪器应已张贴在代表公司为买方及其代表维护的电子数据站点上,买方及其代表已获准进入载有此类信息的电子文件夹。
10.15对应方。本协议及每一份附属文件可由一个或多个对应方签署和交付(包括以传真、pdf或其他电子传输方式),也可由本协议的不同缔约方以不同的对应方签署和交付,每一份协议在签署时应视为原件,但所有这些文件加在一起应构成同一份协议。
10.16采购人代表。
(a)买方代表其本身及其附属公司、承继人及受让人,通过签署及交付本协议,现不可撤销地委任作为买方代表的保证人,作为每名该等人士的代理人、事实上的代理人及代表,并全权代为以该等人士的名义、地点及代为行事,自收市起及之后代表该等人士行事,以处理以下事宜:(i)控制及作出任何有关股份价格目标是否已达成及将根据第1.3条发行盈利股份的决定;(ii)终止,代表该人修订或放弃本协议的任何条款或买方代表作为当事方或以该身份享有其他权利的任何附属文件(连同本协议,“买方代表文件”);(iii)代表该人签署与任何买方代表文件引起的任何争议或补救有关的任何释放文件或其他文件;(iv)聘请并获得法律顾问、会计师和其他专业顾问作为买方代表的意见,行使其合理酌处权,(五)承担和支付合理的自付费用和开支,包括根据本协议所设想的交易而支付的经纪人、律师和会计师的费用,以及任何其他可分配的或以任何方式与此种交易有关的自付费用和开支;(六)以其他方式强制执行任何买方代表文件所规定的任何该等人的权利和义务,包括代表该等人发出和接收根据本协议或根据本协议发出的所有通知和通讯;双方承认,买方代表得到特别授权和指示,可代表买方证券持有人(卖方及其各自的继承人和受让人除外)行事,并为买方证券持有人的利益行事。买方代表的所有决定和行动,包括买方代表和卖方代表之间的任何协议,均对买方及其子公司、继承人和受让人具有约束力,他们或任何其他方均无权对此提出反对、异议、抗议或以其他方式提出异议。第10.16节的规定是不可撤销的,并附带利息。买方代表特此接受其作为本协议规定的买方代表的任命和授权。
(b)买方代表不应对作为买方代表的任何买方代表文件中所作或不作的任何行为负责任,而该文件是本着诚意行事,没有故意的不当行为或重大过失,而根据律师的意见所作或不作的任何行为,应是此种诚意的确凿证据。买方代表(以买方代表的身份)在没有重大过失、恶意或故意不当行为的情况下,因接受或管理买方代表在任何买方代表文件下的职责而产生或与之相关的任何和所有损失,包括买方代表聘请的任何法律顾问的合理费用和开支,买方代表应向买方代表作出赔偿,为其辩护,并使其免受损害。在任何情况下,作为买方代表的买方代表均不应根据或与任何买方代表文件有关而对任何间接、惩罚性、特别或间接损害承担赔偿责任。买方代表在依赖其真诚地认为是真实的任何书面通知、要求、证书或文件,包括其传真或副本时,应得到充分保护,任何人对以上述方式依赖买方代表不负任何责任。在履行本合同规定的权利和义务时,买方代表有权随时和不时选择和聘用,费用和
A-50
买方、律师、会计师、投资银行家、顾问、顾问和文书人员的费用,并获得买方代表不时认为必要或适当的其他专业和专家协助,保存记录和产生其他自付费用。根据本条第10.16款授予买方代表的所有赔偿、豁免、释放和权力应在截止日期后继续有效,并无限期持续下去。
(c)担任买方代表的人可在提前十(10)天向买方和卖方代表发出书面通知后辞职,但须由买方代表以书面指定一名替代买方代表。每一位继任买方代表应享有本协定赋予原买方代表的一切权力、权力、权利和特权,本协定所用的“买方代表”一词应视为包括任何此类继任买方代表。
10.17卖方代表。
(a)在签署和交付本协议时,每一卖方代表其本身及其继承人和受让人,在此不可撤销地构成并指定Deven Patel作为卖方代表,作为这些人的真实和合法的代理人和实际代理人,这些人有完全的替代权以其名义行事,根据本协议及卖方代表作为当事方或以其他身份享有权利的附属文件(连同本协议,称为“卖方代表文件”)的条款和规定,代表该人履行任何进一步的行为和事情,以及代表该人执行任何此类文件(如有的话),卖方代表认为与卖方代表文件所设想的任何交易有关的必要或适当的交易,包括:(i)控制和决定是否已实现股价目标和根据第1.3节发行收益股票;(ii)代表该人终止、修订或放弃任何卖方代表文件的任何规定(条件是,任何此类行动,如果卖方代表的合理判断对卖方的权利和义务具有重大影响,将以同样的方式对待所有卖方,除非每一卖方另有约定,而卖方须受到任何可能具有重大和不利性质的不同对待);(iii)代表该人签署与任何卖方代表文件所引起的任何争议或补救有关的任何免责声明或其他文件;(iv)聘请并获得法律顾问、会计师和其他专业顾问作为卖方代表的意见,行使其合理的酌处权,认为在履行其作为卖方代表的职责并依赖卖方代表的意见和顾问时有必要或可取的;(v)产生和支付合理的费用和开支,包括根据本协议所设想的交易而产生的经纪人、律师和会计师的费用,以及可分配的或以任何方式与此种交易有关的任何其他合理的费用和开支,(vi)收取根据本协议向卖方提供的全部或任何部分代价,并按照卖方的按比例份额向卖方分配该代价;及(vii)以其他方式强制执行任何该等人士在任何卖方代表文件下的权利和义务,包括代表该等人士发出和接收根据本协议或根据本协议发出的所有通知和通讯。卖方代表的所有决定和行动,包括卖方代表和买方代表之间的任何协议,均对每一卖方及其各自的继承人和受让人具有约束力,他们或任何其他方均无权对此提出反对、异议、抗议或以其他方式提出异议。第10.17节的规定是不可撤销的,并附带利息。卖方代表特此接受其作为本协议规定的卖方代表的任命和授权。
(b)任何其他人,包括买方代表、买方和本公司,均可在不经调查的情况下,将卖方代表的任何行为作为卖方根据任何卖方代表文件所作的行为,确凿而绝对地依赖于卖方代表的任何行为。买方代表、买方和本公司有权在以下方面最终依赖卖方代表的指示和决定:(一)根据第1.3节解决与股价目标有关的任何争议;(二)卖方代表提供的任何付款指示;或(三)卖方代表根据本协议要求或允许采取的任何其他行动;卖方不得对买方代表有任何诉讼理由,买方或本公司根据卖方代表的指示或决定采取的任何行动。买方代表、买方和本公司对卖方代表向卖方代表支付或按照卖方代表的指示在卖方之间分配或分配付款不承担任何责任。根据任何卖方代表文件要求向卖方发出或交付的所有通知或其他通信,均应为卖方代表的利益而向卖方代表发出,而如此发出的任何通知均应充分履行本协议或本协议其他各方就此向卖方发出的所有通知要求。卖方必须发出或交付的所有通知或其他通信均应由卖方代表发出(第10.17(d)节中关于更换卖方代表的通知除外)。
A-51
(c)卖方代表将以卖方代表认为最符合卖方利益的方式代表卖方处理本协议所列的所有事项,但卖方代表不对卖方因卖方代表履行本协议规定的卖方代表职责而可能遭受的任何损失负责,但因卖方代表在履行本协议规定的职责时的恶意、重大过失或故意不当行为而造成的损失除外。自交易结束后,买方应就卖方代表(以买方代表的身份)在没有重大过失、恶意或故意不当行为的情况下,因卖方代表根据任何卖方代表文件接受或管理卖方代表的职责,包括卖方代表聘请的任何法律顾问的合理费用和开支而合理招致的任何和所有损失,向卖方代表作出赔偿,为其辩护,并使其免受损害。在任何情况下,以该身份的卖方代表均不对任何间接、惩罚性、特殊或间接损害承担责任。卖方代表不应对作为卖方代表的任何卖方代表文件中所做或不做的任何行为承担责任,而这些行为是善意的,没有故意的不当行为或重大过失,并且根据律师的意见所做或不做的任何行为应是此种善意的确凿证据。卖方代表在依赖其真诚地认为是真实的任何书面通知、要求、证书或文件,包括传真或副本时,应受到充分保护,任何人对以上述方式依赖卖方代表不承担任何责任。在履行其在本合同项下的权利和义务时,卖方代表有权在买方合理的费用和开支范围内,随时选择和聘用律师、会计师、投资银行家、顾问、顾问和文书人员,并获得卖方代表合理地认为必要或适当的其他专业和专家协助,保存记录,并承担其他合理的自付费用。根据本条第10.17款授予卖方代表的所有赔偿、豁免、释放和权力应在截止日期后继续有效,并无限期持续下去。
(d)如果卖方代表死亡、残疾、解散、辞职或因其他原因无法或不愿履行其作为卖方代表和代理人的职责,则卖方应在死亡、残疾、解散、辞职或其他事件发生后十(10)天内指定一名继任卖方代表(通过投票或卖方书面同意合计持有超过百分之五十(50%)的按比例分配股份),并在其后迅速(但无论如何在指定后两(2)个工作日内)以书面形式通知买方代表和买方该继任者的身份。为本协议的目的,任何如此指定的继承人应成为“卖方代表”。
10.18法律代表。
(a)双方同意,尽管EGS在交割前可能就本协议、附属文件和本协议所设想的交易共同代表买方、买方代表和/或保荐人,并且在涉及本协议标的交易以外的事项上也代表买方和/或其关联公司,但EGS在交割后仍将被允许代表保荐人,买方代表或其各自的附属公司处理此种人对买方或其任何附属公司不利的事项,包括因本协议而产生或与本协议有关的任何争端。本公司、卖方和卖方代表,凡在本协议所设想的交易中由独立律师代表或有权由独立律师代表的,特此事先同意放弃(并促使其关联公司放弃)EGS未来为一名或多名保荐人、买方代表或其各自关联公司的代表而可能产生的任何实际或潜在的利益冲突,如果这些人的利益不利于买方、本公司的利益,卖方和/或卖方代表或他们各自的任何关联公司,包括因本协议而产生的任何事项,或与本协议或EGS对买方、保荐人、买方代表或他们各自的任何关联公司的任何先前代理有实质性关系的任何事项。双方承认并同意,就律师-委托人特权而言,在本协议及附属文件的谈判、执行和履行方面,担保人和买方代表应被视为EGS的客户。所有此类通信在交割后仍享有特权,与此相关的特权和对客户信任的期望应完全属于保证人和买方代表,应由保证人和买方代表控制,不得传递给买方或目标公司,或由买方或目标公司提出要求;此外,本协议中的任何内容均不得被视为买方或其任何关联公司的放弃(包括在交割后,目标公司及其各自的关联公司)可以或可能主张的任何适用特权或保护,以防止向任何第三方披露任何此类通信。
(b)双方同意,尽管Winston & Strawn LLP(“W & S”)可能在交割前就本协议、附属文件和本协议所设想的交易共同代表本公司、卖方代表和卖方,并就本协议所述交易以外的事项代表本公司和(或)其关联公司,但W & S今后将获准在
A-52
交割,代表卖方代表、卖方或其各自的关联公司处理此类人对本公司或其任何关联公司不利的事项,包括因本协议产生或与本协议相关的任何争议。买方和买方代表各自就本协议所设想的交易由独立律师代理或有权由独立律师代理,在此事先同意放弃(并促使其关联公司放弃)与W & S未来代理卖方代表、卖方或其各自关联公司中的一人或多人的利益损害买方利益有关的任何实际或潜在利益冲突,买方代表和/或本公司或其任何关联公司,包括因本协议而产生的任何事项,或与本协议或W & S对本公司、卖方代表、卖方或其任何关联公司的任何先前代理有实质性关系的任何事项。双方承认并同意,就律师-委托人特权而言,卖方代表和卖方在本协议及附属文件的谈判、执行和履行方面应被视为W & S的客户。所有此类通信在交易结束后仍应享有特权,与此相关的特权和客户信任的期望应完全属于卖方代表和卖方,应由卖方代表和卖方控制,不得传递给买方或目标公司,或由买方或目标公司提出要求;但本协议中的任何内容均不得被视为公司或其任何关联公司的放弃(包括,在交易结束后,买方及其附属公司)可以或可能主张的任何适用特权或保护,以防止向任何第三方披露任何此类通信。
XI
定义
11.1某些定义。为本协定的目的,下列大写术语具有以下含义:
“AAA”指的是美国仲裁协会或进行仲裁的任何后续实体。
“行动”是指任何不遵守或违规的通知,或任何索赔、要求、指控、行动、诉讼、诉讼、审计、和解、投诉、规定、评估或仲裁,或任何政府当局提出的任何请求(包括任何信息请求)、调查、听证、程序或调查。
就任何人而言,“关联”指直接或间接控制、受其控制或与其共同控制的任何其他人。为免生疑问,保荐人应被视为交易结束前的关联公司或买方。
“附属文件”是指作为证物附于本协议的每一份协议、文书或文件,以及本协议任何一方就本协议或根据本协议签署或交付的其他协议、证书和文书。
任何人的“福利计划”是指任何和所有递延薪酬、高管薪酬、激励性薪酬、股权购买或其他基于股权的薪酬计划、雇佣或咨询、遣散费或解雇费、假期、假期或其他奖金计划或实践、住院或其他医疗、人寿或其他保险、补充失业福利、利润分享、养老金或退休计划、计划、协议、承诺或安排,以及其他员工福利计划、计划、协议或安排,包括ERISA第3(3)节定义的每个“员工福利计划”,为该人的任何雇员或被解雇的雇员的利益而维持或向该人供款或须由该人供款,或该人对此负有任何责任,不论是直接或间接的、实际的或或有的,不论是正式或非正式的,亦不论是否具有法律约束力。
“营业日”是指除周六、周日或法定假日以外的任何一天,纽约、纽约的商业银行机构有权停业,但不包括由于“待在家里”、“就地避难”、“非必要员工”或任何其他类似命令或限制,或在任何政府机构的指示下关闭任何实体分行,只要纽约、纽约的商业银行机构的电子资金转账系统(包括电汇)通常在该日开放供客户使用。
“控制权变更”是指:(a)在交易结束后的任何日期,任何个人或群体(不是买方的关联公司)对买方股本的实益所有权(定义见《交易法》第13(d)节)的任何收购,而该个人或群体已持有的买方股本占买方股本总投票权的百分之五十(50%)以上;但为免生疑问,为本款的目的,收购买方的额外股本(不包括导致一个人或一群人(并非买方的附属公司)拥有买方未偿还股本100%的收购)(i)由
A-53
在此项收购之前实益拥有买方股本总投票权百分之五十(50%)以上的任何人或一组人,(ii)由于任何盈利股份的发行,或(iii)根据保荐人或其附属公司按比例向其各自的股东作出的分配,将不会被视为控制权的变更;或(b)在买方交割后的任何日期,另一人通过(i)任何交易或一系列相关交易(包括任何重组、合并或合并,但不包括专为改变买方住所而进行的任何合并)而进行的任何收购,(ii)出售买方及其附属公司的全部或基本上全部资产,作为一个整体,如果在第(i)或第(ii)条的情况下,买方在紧接该等交易、一系列相关交易或出售之前已发行的股本股份的数目,在紧接该等交易、一系列相关交易或出售之后,占存续或收购实体总投票权的百分之五十(50%)以下。
“法典”是指经修订的1986年《国内税收法》及其任何后续法规。对《守则》某一具体章节的提及,应包括该节和根据该节颁布的任何有效的财务条例。
“公司机密信息”是指与本协议或本协议所设想的交易有关的有关目标公司、卖方或其任何代表的所有机密或专有文件和信息;但公司机密信息不应包括任何信息,这些信息(i)在买方或其代表披露时,通常是公开的,并且在违反本协议的情况下没有披露,或(ii)在公司披露时,a卖方或其各自的买方代表或买方代表先前已被该接收方认识,而接收该公司机密信息的人没有违反法律或任何保密义务。
“公司可转换证券”统称为认购或购买本公司任何股本的任何期权、认股权证或权利,或可转换为或可交换的证券,或以其他方式赋予持有人取得本公司任何股本的任何权利的任何期权、认股权证或权利。为免生疑问,公司可转换证券应包括由任何关联公司、计划、控股公司或直接或间接持有公司证券的其他实体发行的任何证券、权利和/或利润权益,这些证券、权利和/或利润权益可能导致公司证券的重估、估值、发行、利润或支付补偿,或转换、行使或交换。
“公司内幕信息知情人”是指(一)是公司董事或执行官,或(二)合计拥有公司已发行和流通股本至少百分之五(5%)的公司普通股股东。
“公司普通股”是指公司的普通股,每股面值0.0001英镑。
“公司证券”是指公司普通股和任何公司可转换证券的统称。
“同意”是指任何政府机构或任何其他人的同意、批准、放弃、授权或许可、通知、声明或备案。
“合同”是指所有合同、协议、有约束力的安排、债券、票据、契约、抵押、债务工具、定购单、许可证(以及与知识产权有关的所有其他合同、协议或有约束力的安排)、特许经营权、租赁和其他任何种类的书面或口头文书或义务(包括对其的任何修改和其他修改)。
对个人的“控制”是指直接或间接地拥有权力,以指导或促使指导个人的管理和政策,无论是通过对有表决权的证券的所有权,还是通过合同或其他方式。“受控”、“受控”和“在共同控制下”具有相关含义。在不限制上述规定的情况下,任何人(“受控制人”)应被视为由(a)任何其他人控制,(i)根据《交易法》第13d-3条的规定,实益拥有证券,使该人有权为选举董事或受控制人的同等管理权力而投票百分之十(10%)或以上,或(ii)有权获得或获得受控制人利润、亏损或分配的百分之十(10%)或以上;(b)高级职员、董事、普通合伙人、合伙人(有限合伙人除外)、经理,(c)受控制人的配偶、父母、直系后裔、兄弟姐妹、姑姑、姑父、姑父、侄女、侄子、岳母、岳父、弟媳或姐夫,或为受控制人的附属公司或受控制人的附属公司的利益而设立的信托,或受控制人的附属公司为其受托人的信托。
“版权”是指任何具有作者身份的作品,包括面具作品、文字作品、视觉、图片或图形作品,或数据或其他信息的汇编,以及其中的所有版权,包括所有续展和延期、版权登记和注册和续展申请,以及非注册版权。
A-54
“新冠疫情”是指SARS-CoV-2或新冠疫情,以及它的任何演变或任何其他相关或相关的流行病、流行病或疾病爆发。
“新冠疫情措施”是指任何政府机构(包括美国疾病控制中心和世界卫生组织)在与新冠疫情相关、与之相关或为应对新冠疫情而制定的任何隔离措施、“就地避难”、“待在家里”、减少劳动力、保持社交距离、关闭、隔离或任何其他法律、指令、指导方针或建议,包括《冠状病毒援助、救济和经济安全法》(CARES)或其任何修改。
“DGCL”指的是经修订的《特拉华州一般公司法》。
“收益按比例份额”是指,对于每个收益卖方,(a)每个收益卖方的按比例份额除以(b)所有收益卖方的按比例份额总和。
“收益卖方”是指除TAG Partners Ltd.及其受让人和受让人以外的所有卖方。
“环境法”是指以任何方式涉及(a)保护人类健康和安全,(b)保护、保存或恢复环境和自然资源(包括空气、水蒸气、地表水、地下水、饮用水供应、地表土地、地下土地、动植物或任何其他自然资源),或(c)接触或使用、储存、回收、处理、生成、运输、加工、处理、标签、生产、排放或处置危险材料的任何法律,包括南加州大学42号《综合环境应对、赔偿和责任法》。第9601条等,《资源保护和恢复法》,42 USC。第6901等节,《有毒物质控制法》,15 USC。第2601条等,联邦水污染控制法,33 USC。第1151条及以下各条,《清洁空气法》,42 USC。《联邦杀虫剂、杀菌剂和灭鼠剂法》第7401条及以下各条,7 USC。第111条等,《职业安全和健康法》,29 USC。第651条等(在涉及接触有害物质的范围内),《石棉危害应急反应法》,15 USC。第2601条等,《安全饮用水法》,42 USC。第300f条及以下各条、1990年《石油污染法》和类似的国家法令。
“环境责任”是指,对任何人而言,所有的责任、义务、责任、补救行动、损失、损害、成本和开支(包括所有合理的费用、支出、律师、专家和顾问的开支以及调查和可行性研究的费用)、罚款、罚款、处罚和利息,这些费用是由于任何其他人的任何索赔或要求,或由于任何违反环境法的行为而产生的,无论是已知的还是未知的、应计的或有的,无论是基于合同、侵权行为、默示或明示保证、严格的责任、刑事或民事法规,但以基于、相关的,或根据任何环境法、环境许可证、命令或与任何政府当局或其他人签订的合同产生的,与任何环境、健康或安全状况、违反环境法或危险材料的释放或威胁释放有关的。
“ERISA”指的是经修订的1974年美国雇员退休收入保障法。
“ERISA关联公司”是指与目标公司或其任何子公司一起被视为《守则》第414(b)、(c)、(m)或(o)条所指的“单一雇主”的每个人(定义见ERISA第3(9)条)。
“交易法”是指经修订的1934年美国证券交易法。
“FDA”指的是美国食品药品监督管理局(或任何后续的政府机构)。
“欺诈索赔”是指全部或部分基于欺诈、故意不当行为或故意虚假陈述的索赔。
“GAAP”是指在美国生效的公认会计原则。
“政府机构”是指任何联邦、州、地方、非美国或其他政府、准政府或行政机构、机构、部门或机构或任何法院、法庭、行政听证机构、仲裁小组、委员会或其他类似的争端解决小组或机构。
“危险材料”是指根据《环境法》或任何其他受管制的材料,被定义、列出或指定为“危险物质”、“污染物”、“污染物”、“危险废物”、“受管制物质”、“危险化学品”或“有毒化学品”(或任何类似术语)的任何废物、气体、液体或其他物质或材料,或可能导致
A-55
根据任何环境法规定的责任或责任,包括石油及其副产品、石棉、多氯联苯、氡、霉菌和尿素甲醛绝缘材料。
任何人的“负债”是指(a)该人对借款的所有负债(包括未偿还的本金和应计但未支付的利息),(b)对财产或服务的递延购买价格的所有债务(正常经营过程中发生的应付贸易账款除外),(c)该人以票据、债券、债权证、信贷协议或类似文书证明的任何其他债务,(d)该人在按照公认会计原则应归类为资本租赁的租赁下的所有债务,(e)该人就任何信贷额度或信用证、银行承兑汇票、保证或类似信贷交易(在每种情况下)为偿付任何承付人而承担的所有义务,(f)该承付人就已发出或创设的承兑汇票而承担的所有义务,(g)该承付人有义务定期或在意外情况发生时支付款项的所有利率及货币掉期、上限、项圈及类似协议或对冲工具,(h)以该承付人任何财产上的留置权作担保的所有债务,(i)与支付该人的任何债项有关的任何保费、预付费用或其他罚款、费用、讼费或开支,以及(j)上文(a)至(i)条所述由该人直接或间接担保的任何其他人的所有债务,或该人已同意(或有或其他方式)购买或以其他方式取得的任何其他人,或该人已就该等债务向债权人保证免受损失。
“独立专家通知日期”是指一代表方根据第1.3(c)节收到另一代表方将此类争议提交独立专家的书面通知的日期。
“独立专家”系指买方代表和卖方代表任命的相互可接受的独立(即在过去两(2)年内与任何一方没有实质性业务关系)专家会计师事务所,其任命将不迟于独立专家通知日期后十(10)天内作出;但如果独立专家不接受其任命,或如果代表双方无法就独立专家达成一致,则在独立专家通知日期后二十(20)天内,任何一方代表均可要求,通过书面通知另一代表方,独立专家由AAA的纽约市地区办事处按照AAA的程序选出。当事各方同意,即使某一缔约方或其附属机构今后可指定独立专家解决第1.3(d)节所述类型的争端,独立专家也将被视为独立专家。
“知识产权”是指在世界各地的任何司法管辖区存在的以下所有内容:专利、商标、版权、商业秘密、互联网资产、软件和其他知识产权,以及与上述财产有关的所有许可、分许可和其他协议或许可。
“互联网资产”是指任何和所有的域名注册、网站和网址以及与之相关的权利、项目和文件,以及注册申请。
“首次公开发行”是指根据《首次公开发行招股说明书》进行的买方单位首次公开发行。
“IPO招股说明书”是指买方于2021年11月8日提交给美国证券交易委员会的最终招股说明书(文件编号:257369)。
“IPO承销商”是指Cantor Fitzgerald & Co.,作为IPO承销商的代表。
“IRS”指的是美国国税局(或任何后续的政府机构)。
“知悉”是指,就(i)本公司而言,目标公司的执行人员或董事经合理查询后实际知悉的情况,或(ii)任何其他方;(A)如属实体,则指其董事或执行人员经合理查询后实际知悉的情况;或(B)如属自然人,指该等方经合理查询后实际知悉的情况。
“法律”指任何联邦、州、地方、市、外国或其他法律、法规、立法、普通法原则、法令、法典、法令、法令、公告、条约、公约、规则、条例、指令、要求、令状、强制令、和解、命令或同意,由或在任何政府当局的授权下发布、颁布、通过、通过、批准、颁布、实施或以其他方式生效。
“负债”是指任何和所有的负债、债务、行动或任何性质的义务(无论是绝对的、应计的、或有的或其他的、已知的或未知的、直接的或间接的、到期的或未到期的、到期的或
A-56
根据公认会计原则或其他适用的会计准则,是否需要记录或反映在资产负债表上),包括到期或即将到期的税务负债。
“留置权”是指任何抵押、质押、担保权益、扣押、优先购买权、选择权、代理权、表决权信托、产权负担、留置权或任何种类的押记(包括任何有条件的出售或其他所有权保留协议或其性质的租赁)、限制(无论是在投票、出售、转让、处分或其他方面)、有利于另一人的从属安排,或根据《统一商法典》或任何类似法律作为债务人提交融资声明的任何备案或协议。
“损失”是指任何和所有的损失、诉讼、命令、责任、损害赔偿、税收、利息、罚款、留置权、和解支付的金额、成本和费用(包括合理的调查和法庭费用以及合理的律师费和费用)。
就任何特定人士而言,“重大不利影响”是指任何事实、事件、发生、变更或影响,已对(a)该人士及其附属公司作为一个整体的业务、资产、负债、经营、经营成果、前景或状况(财务或其他方面)单独或合计产生或合理预期将产生重大不利影响,(b)该人或其任何附属公司有能力及时完成本协议或其作为当事方或受其约束的附属文件所设想的交易,或履行其在本协议下或根据本协议承担的义务;但就上文(a)款而言,任何直接或间接可归因于、产生于、与之有关或产生于以下各项的变动或影响(本身或当与任何其他变动或影响合并时),不应被视为构成,或在确定是否存在或可能、将会或可能已经发生重大不利影响时考虑到:(i)金融或证券市场的一般变化,或在该人或其任何附属公司经营业务的国家或地区的一般经济或政治条件;(ii)变化,一般影响该人或其任何附属公司主要经营所在行业的条件或影响;(iii)适用法律(包括新冠疫情措施)或公认会计原则或其他适用会计原则的变更,或适用于该人及其附属公司主要经营所在行业的监管会计要求的强制性变更;(iv)天灾、恐怖主义、战争(无论是否宣示)(包括俄罗斯入侵乌克兰或任何周边国家)造成的条件,自然灾害或大流行病(包括新冠疫情)或其恶化;(v)该人及其附属公司本身未能满足任何期间的内部或已公布的预算、预测、预测或财务执行情况预测(但在确定是否已发生或合理预期会发生重大不利影响时,可考虑任何此类失败的根本原因,其程度不在本文另一例外情况所排除的范围内)和(vi)对买方而言,任何赎回的完成和影响;但前提是任何事件、发生、事实,上述第(i)-(iv)条所述的条件或变更,在确定是否已发生或可合理地预期会发生重大不利影响时,须予考虑,但该等事件、发生、事实、条件或变更对该人或其任何附属公司的影响,与该人或其任何附属公司主要经营其业务的行业的其他参与者相比,不成比例。尽管如此,就买方而言,任何赎回或未能获得所需买方股东批准或赎回时效修订的金额不应被视为对买方或就买方而言的重大不利影响。
“全国交易所”是指根据《交易法》第6(a)条在SEC注册的任何美国证券交易所,包括纽约证券交易所、纳斯达克、纽约证券交易所美国或任何类似的交易所。
“纽约证券交易所”指的是纽约证券交易所。
“命令”是指由任何政府当局或在其授权下作出或已经作出、订立、作出或以其他方式生效的任何命令、法令、裁决、判决、强制令、令状、裁定、具有约束力的决定、裁决、司法裁决或其他行动。
“组织文件”是指,对于任何一个实体的人,其注册或成立证书、章程、经营协议、组织章程大纲和章程细则或类似的组织文件,在每种情况下均经修订。
“专利”是指任何专利、专利申请以及其中描述和主张的发明、设计和改进、可申请专利的发明和其他专利权(包括任何分立、临时、延续、部分延续、替换、重新审查的专利或重新发布,无论是否就任何此类申请发布专利,以及是否对任何此类申请进行修改、修改、分割、继续、放弃、撤回或重新提交)。
“PCAOB”是指美国上市公司会计监督委员会(或其任何后续机构)。
A-57
“许可”指所有联邦、州、地方或外国或其他第三方许可、授权、地役权、同意、批准、授权、豁免、许可、特许、特许权、批准、许可、许可、确认、背书、豁免、认证、指定、评级、注册、资格或任何政府当局或任何其他人的命令。
“准许留置权”是指(a)对税款或摊款及类似的政府收费或征费的留置权,这些留置权要么(i)没有拖欠,要么(ii)出于善意和通过适当的程序提出异议,并已就此设立了足够的准备金,(b)在正常经营过程中因法律的实施而施加的其他留置权,这些留置权是针对在正常经营过程中产生的未到期和应付的款项,而且这些款项的总额不会对受其管辖的财产的价值产生重大不利影响,或对其使用产生重大不利影响,(c)在正常经营过程中与社会保障有关的留置权或存款;(d)在正常经营过程中产生的依据跟单信用证产生的过境货物留置权;或(v)根据本协议或任何附属文件产生的留置权。
“人”是指个人、公司、合伙企业(包括普通合伙企业、有限合伙企业或有限责任合伙企业)、有限责任公司、协会、信托或其他实体或组织,包括政府、国内外或其政治分支机构,或其机构或工具。
“个人财产”是指任何机器、设备、工具、车辆、家具、租赁物改良、办公设备、厂房、零件和其他有形的个人财产。
“买方A类普通股”是指买方的A类普通股,每股面值0.0001美元。
“买方B类普通股”是指买方持有的B类普通股,每股面值0.0001美元。
“买方普通股”是指买方A类普通股和买方B类普通股的合称。为免生疑问,本协议中任何在交易结束后提及买方普通股的内容,均指买方A类普通股。
“买方机密信息”是指与买方或其任何代表有关的所有机密或专有文件和信息,但前提是买方机密信息不应包括以下任何信息:(i)在公司、任何卖方、卖方代表或其任何代表披露时,这些信息通常是公开的,并且在违反本协议的情况下没有披露,或(ii)在买方或其代表向公司、任何卖方、卖方代表或他们各自的代表披露时,该接收方在没有违反法律或任何保密义务的情况下事先知晓此种买方机密信息的接收方。为免生疑问,自交易结束后,买方机密资料将包括目标公司的机密或专有资料。
“买方优先股”是指买方的优先股,每股面值0.0001美元。
“买方私人认股权证”是指在IPO完成时,买方以私募方式向保荐人和IPO承销商发行的一整份不可赎回的认股权证,该认股权证的持有人有权以每股11.50美元的购买价格购买一(1)股买方A类普通股。
“买方公开认股权证”是指作为每个买方单位的一部分而包含的二分之一(½)认股权证中的一整份可赎回认股权证,该认股权证的持有者有权以每股11.50美元的购买价格购买一(1)股买方A类普通股。
“买方证券”是指买方单位、买方普通股、买方优先股和买方认股权证的统称。
“买方单位”是指在IPO中发行的单位(包括IPO承销商获得的超额配售单位),包括一(1)股买方A类普通股和一份买方公开认股权证的二分之一(½)。
“买方认股权证”是指买方私人认股权证和买方公开认股权证的统称。
“赎回价格”是指买方A类普通股的每一股根据收盘时赎回或转换的价格(根据收盘后股票分割、股票股息、合并、资本重组等进行公平调整)。
A-58
“释放”是指任何释放、溢出、排放、泄漏、泵送、注入、沉积、处置、排放、分散或浸入室内或室外环境,或进入或流出任何财产。
“补救行动”是指为(i)清理、清除、处理或以任何其他方式处理任何危险材料,(ii)防止任何危险材料的释放,使其不危及或威胁危害公众健康或福利或室内或室外环境,(iii)进行补救前研究和调查或补救后监测和护理,或(iv)纠正不遵守环境法的情况而采取的所有行动。
就任何人而言,“代表”是指该人的附属公司以及该人或其附属公司各自的经理、董事、高级职员、雇员、独立订约人、顾问、顾问(包括财务顾问、法律顾问及会计师)、代理人及其他法律代表。
“SEC”指的是美国证券交易委员会(或任何后续的政府机构)。
《证券法》是指经修订的1933年《证券法》。
“重要卖方”是指(i)是本公司的执行官或董事或(ii)拥有本公司已发行和已发行股份百分之五(5%)以上的任何卖方。
“软件”是指任何计算机软件程序,包括所有源代码、对象代码、相关文档以及所有软件模块、库、存储库、工具和数据库。
“SOX”指的是经修订的2002年美国《萨班斯-奥克斯利法》。
“赞助商”指Apeiron Capital赞助商有限责任公司,一家特拉华州的有限责任公司。
就任何人而言,“附属公司”指任何公司、合伙企业、协会或其他商业实体,其中(i)如属公司,则在选举董事、经理或受托人时,有权(不考虑任何意外情况)投票的股份的总投票权的多数,在当时由该人或该人的一个或多个其他附属公司或其组合直接或间接拥有或控制,或(ii)如属合伙企业、协会或其他商业实体,该合伙企业或其其他类似所有权权益的多数在当时由任何人或该人的一个或多个子公司或其组合直接或间接拥有或控制。为本协议的目的,一个人或多个人将被视为在合伙企业、协会或其他商业实体中拥有多数股权,如果这些人或多个人将获得合伙企业、协会或其他商业实体的多数收益或损失,或将成为或控制该合伙企业、协会或其他商业实体的董事总经理、管理成员、普通合伙人或其他管理人员。一个人的子公司还将包括根据适用的会计规则与该人合并的任何可变利益实体。
“目标公司”指公司及其直接和间接子公司。
“纳税申报表”是指为确定、评估或征收任何税款或执行与任何税款有关的法律或行政要求而提交或要求提交的任何纳税申报表、声明、报告、退款要求、信息申报表或其他文件(包括任何相关或配套的附表、报表或信息)。
“税”是指(a)所有直接或间接的联邦、州、地方、外国和其他方面的净收入、总收入、总收入、销售、使用、增值、从价、转让、特许经营、利润、许可证、租赁、服务、服务使用、代扣代缴、工资、就业、社会保障和与向雇员支付补偿、消费税、遣散费、印花、职业、保费、财产、意外利润、替代性最低标准、估计、关税、关税或其他任何种类的税、费、评估或收费,以及任何利息和任何罚款、增税或额外金额,(b)支付(a)条所述款额的任何法律责任,不论是由于在任何期间内是附属、合并、合并或统一集团的成员,或由于法律的实施而导致;及(c)由于与任何其他人订立的分税、分税、分税或分税协议,或任何其他明示或默示的弥偿协议而支付(a)或(b)条所述款额的任何法律责任。
“商业秘密”是指任何商业秘密、机密商业信息、概念、想法、设计、研究或开发信息、工艺、程序、技术、技术信息、规格、操作和维护手册、工程
A-59
图纸、方法、技术诀窍、数据、面具作品、发现、发明、修改、扩展、改进和其他所有权(无论是否可申请专利或受版权、商标或商业秘密保护)。
“商标”是指任何商标、服务标志、商业外观、商品名称、品牌名称、互联网域名、设计、标识或公司名称(在每种情况下,包括与之相关的商誉),无论是否已注册,以及所有注册和申请注册和续展。
“交易日”是指买方A类普通股股票在买方A类普通股股票交易的主要证券交易所或证券市场实际交易的任何一天。
“信托账户”是指买方根据《信托协议》根据《首次公开发行说明书》以首次公开发行募集资金设立的信托账户。
“信托协议”是指买方与受托人之间于2021年11月8日签署并可能修订的某些投资管理信托协议,以及与信托账户相关或管辖信托账户的任何其他协议。
“受托人”是指大陆证券股份转让信托公司,根据信托协议,该公司是受托人。
就任何证券而言,“VWAP”是指在纽约时间上午9:30:01开始至纽约时间下午4:00结束期间,该证券在纽约时间上午9:30:01开始至纽约时间下午4:00结束的主要证券交易所或证券市场上的美元成交量加权平均价格,如彭博通过其“惠普”功能(设为加权平均)报告,或在不适用上述规定的情况下,该证券在纽约时间上午9:30:01开始的期间,在该证券的电子公告板上的场外市场上的美元成交量加权平均价格,并在纽约时间下午4:00:00结束,如彭博报道,或如彭博在该时段内没有报告此类证券的美元成交量加权平均价格,则为OTC Markets Group Inc.报告的此类证券的任何做市商的最高收盘价和最低收盘价的平均值。如果无法根据上述任何一种基准在该日期计算此类证券的VWAP,该证券在该日期的VWAP,应是由适用发行人的董事会(或同等理事机构)中的多数无私独立董事合理和善意地确定的公允市场价值。在此期间,所有这些决定都应针对任何股票股息、股票分割、股票合并、资本重组或其他类似交易进行适当调整。
“WARN法案”是指经修订的1988年《工人调整和再培训通知法》,或任何类似的联邦、州、地方或外国法律。
11.2部分参考资料。在本协定中使用的下列大写术语具有与这些术语相邻的下文节中赋予它们的各自含义:
任期 |
|
科 |
|---|---|---|
2022年公司财务 |
6.4(a) |
|
AAA程序 |
10.6 |
|
收购建议书 |
6.6(a) |
|
协议 |
序言 |
|
替代交易 |
6.6(a) |
|
经修订的买方组织文件 |
1.4 |
|
反垄断法 |
6.9(b) |
|
业务组合 |
9.1 |
|
首席财务官 |
1.3(c) |
|
收盘 |
2.1 |
|
截止日期 |
2.1 |
|
截止备案 |
6.12(b) |
|
闭幕新闻稿 |
6.12(b) |
|
结束赎回 |
6.11(a) |
|
公司 |
序言 |
|
公司福利计划 |
4.19(a) |
|
公司证书 |
1.5 |
|
公司披露时间表 |
第四条 |
|
公司财务 |
4.7(a) |
|
公司知识产权 |
4.13(d) |
A-60
任期 |
|
科 |
|---|---|---|
公司知识产权许可证 |
4.13(a) |
|
公司物资合同 |
4.12(a) |
|
公司许可证 |
4.10 |
|
公司个人财产租赁 |
4.16 |
|
公司不动产租赁 |
4.15 |
|
公司注册知识产权 |
4.13(a) |
|
公司重组 |
6.20(b) |
|
D & O获弥偿人士 |
6.16(a) |
|
D & O尾部保险 |
6.16(b) |
|
董事 |
6.15(a) |
|
争议 |
10.6 |
|
盈利期 |
1.3(a) |
|
盈利股票 |
1.3(a) |
|
收益报表 |
1.3(c) |
|
EGS |
2.1 |
|
就业协议 |
6.19 |
|
可执行性例外 |
3.2 |
|
环境许可证 |
4.20(a) |
|
交换考虑 |
1.2 |
|
交换股份 |
1.2 |
|
费用 |
8.3 |
|
延期费用 |
6.3(b)(四) |
|
延期赎回 |
3.5(b) |
|
FDCA |
4.24(a) |
|
联邦证券法 |
6.7 |
|
融资协议 |
6.18 |
|
GIOSTAR供应协议 |
6.20(a) |
|
GS协议 |
6.20(a) |
|
医疗保健法 |
4.24(a) |
|
奖励计划 |
6.11(c) |
|
过渡期 |
6.1(a) |
|
投资公司法 |
3.15 |
|
加入卖家 |
序言 |
|
最新资产负债表日期 |
4.7(a) |
|
锁定协议 |
独奏会 |
|
遗失证明书法定声明 |
1.5 |
|
非竞争协定 |
独奏会 |
|
现成软件 |
4.13(a) |
|
外发知识产权许可证 |
4.13(c) |
|
外部日期 |
8.1(b) |
|
缔约方(ies) |
序言 |
|
交易结束后采购人委员会 |
6.15(a) |
|
按比例分摊 |
1.2 |
|
代理声明 |
6.11(a) |
|
公共认证 |
3.6(a) |
|
公众股东 |
9.1 |
|
购买股份百分比 |
1.2 |
|
购买的股票 |
1.1 |
|
买方 |
序言 |
|
买方披露时间表 |
第三条 |
|
买方财务 |
3.6(b) |
|
买方材料合同 |
3.13(a) |
|
采购人代表 |
序言 |
|
买方代表文件 |
10.16(a) |
|
采购人特别会议 |
6.11(c) |
|
赎回 |
3.5(b) |
|
赎回时效修订 |
6.11(c) |
|
注册声明 |
6.11(a) |
|
相关人士 |
4.21 |
|
已解除的索赔 |
9.1 |
|
释放人员 |
9.2 |
|
代表党 |
1.3(c) |
A-61
任期 |
|
科 |
|---|---|---|
所需的买方股东批准 |
7.1(a) |
|
决议期限 |
10.6 |
|
美国证交会报告 |
3.6(a) |
|
SEC SPAC会计变更 |
3.6(a) |
|
第409A款计划 |
4.19(k) |
|
卖方联合 |
序言 |
|
卖方登记权协议 |
独奏会 |
|
卖方代表 |
序言 |
|
卖方代表文件 |
10.17(a) |
|
卖家 |
序言 |
|
股票交换 |
独奏会 |
|
股价目标 |
1.3(a)(三) |
|
签署文件 |
6.12(b) |
|
签署新闻稿 |
6.12(b) |
|
签署卖方 |
序言 |
|
指定法院 |
10.7 |
|
股东批准事项 |
6.11(c) |
|
一级市场股价目标 |
1.3(a)(一) |
|
二级市场股价目标 |
1.3(a)(二) |
|
Tier III股价目标 |
1.3(a)(三) |
|
交易融资 |
6.18 |
|
触发事件 |
1.3(b) |
|
触发交易价格 |
1.3(b) |
|
投票协议 |
独奏会 |
|
W & S |
10.18(b) |
[ REMAINDER OF PAGE INTENTIONALLY LEFT BLANK;SIGNATURE PAGE FOLLOWS ]
A-62
作为证据,本协议各方已于上述日期签署并交付本业务合并协议。
|
买方: |
|
|
|
|
|
Apeiron Capital Investment Corp. |
|
|
|
|
|
签名: |
Joel Shulman |
|
|
姓名:Joel Shulman |
|
|
职衔:首席执行官 |
|
|
|
|
买方代表: |
|
|
|
|
|
Apeiron Capital担保有限责任公司,仅以买方代表的身份 |
|
|
|
|
|
签名: |
Joel Shulman |
|
|
姓名:Joel Shulman |
|
|
头衔:管理成员 |
[业务合并协议签署页]
作为证据,本协议各方已于上述日期签署并交付本业务合并协议。
|
公司: |
|
|
|
|
|
GIO世界健康有限公司。 |
|
|
|
|
|
签名: |
Chris Paget |
|
|
姓名:克里斯·佩吉特 |
|
|
职务:董事总经理 |
|
|
|
|
卖方代表: |
|
|
|
|
|
Deven Patel |
|
|
Deven Patel,仅以卖方代表的身份 |
|
[业务合并协议签署页]
|
签署卖方: |
||
|
|
||
|
全球干细胞治疗研究所和研究公司。 |
||
|
|
||
|
签名: |
Deven Patel |
|
|
|
姓名:Deven Patel |
|
|
|
职务:首席执行官 |
|
|
|
||
|
|
通知地址: |
|
|
|
||
|
|
GIOSTAR公司。 |
|
|
|
Attn:Deven Patel |
|
|
|
邮政信箱270575 |
|
|
|
圣迭戈,加利福尼亚州 92198 |
|
|
|
电话号码: |
|
|
|
电子邮件: |
|
|
|
||
|
泰格伙伴有限公司。 |
||
|
|
||
|
签名: |
/s/Amal Sharma |
|
|
|
姓名:Amal Sharma |
|
|
|
职务:首席执行官 |
|
|
|
||
|
|
通知地址: |
|
|
|
||
|
|
泰格伙伴有限公司。 |
|
|
|
国际之家 |
|
|
|
24霍尔本高架桥 |
|
|
|
伦敦,EC1A2BN,英国 |
|
|
|
电话: |
|
|
|
|
|
|
|
电子邮件: |
|
|
|
||
[业务合并协议签署页]
|
签署卖方: |
|
|
|
Deven Patel |
|
德文·帕特尔 |
|
|
|
|
通知地址: |
|
|
|
|
|
德文·帕特尔 邮政信箱270575 圣迭戈,加利福尼亚州 92198 电话号码: 电子邮件: |
|
|
||
|
|
||
|
/s/Anand Srivastava博士 |
||
|
博士。 |
阿南德·斯里瓦斯塔瓦 |
|
|
|
||
|
|
通知地址: |
|
|
|
||
|
|
Anand Srivastava博士 |
|
|
|
地址: |
|
|
|
|
|
|
|
电话: |
|
|
|
电子邮件: |
|
[业务合并协议签署页]
附件一
卖方名单
卖方名称 |
|
编号 |
|
百分比 |
|
当前 |
|
当前 |
|
||||
签署卖方 |
|
|
|
|
|
|
|
|
|
|
|
|
|
全球干细胞治疗研究所和研究公司。 |
|
|
17,000,000 |
|
|
67.118 |
% |
|
68.000 |
% |
|
81.731 |
% |
泰格伙伴有限公司。 |
|
|
4,200,000 |
|
|
16.582 |
% |
|
16.800 |
% |
|
0.000 |
% |
德文·帕特尔 |
|
|
1,900,000 |
|
|
7.501 |
% |
|
7.600 |
% |
|
9.135 |
% |
Anand Srivastava博士 |
|
|
1,900,000 |
|
|
7.501 |
% |
|
7.600 |
% |
|
9.135 |
% |
签署卖方持有的合计 |
|
|
25,000,000 |
|
|
98.703 |
% |
|
100.000 |
% |
|
100.000 |
% |
|
|
|
|
|
|
|
|
|
|
|
|
|
|
其他公司股东 |
|
|
|
|
|
|
|
|
|
|
|
|
|
苏雷什·德奥普拉 |
|
|
210,000 |
|
|
0.829 |
% |
|
0.000 |
% |
|
0.000 |
% |
阿尼尔·阿内亚 |
|
|
20,000 |
|
|
0.079 |
% |
|
0.000 |
% |
|
0.000 |
% |
拉姆·巴赫提 |
|
|
20,000 |
|
|
0.079 |
% |
|
0.000 |
% |
|
0.000 |
% |
杰西·David Mitchell |
|
|
20,000 |
|
|
0.079 |
% |
|
0.000 |
% |
|
0.000 |
% |
尼哈尔·德奥普拉 |
|
|
13,000 |
|
|
0.051 |
% |
|
0.000 |
% |
|
0.000 |
% |
钱德拉普拉卡什·纳姆瓦尔 |
|
|
10,000 |
|
|
0.039 |
% |
|
0.000 |
% |
|
0.000 |
% |
森博·皮莱 |
|
|
10,000 |
|
|
0.039 |
% |
|
0.000 |
% |
|
0.000 |
% |
Priyanka Amreesh Jhanwar |
|
|
8,000 |
|
|
0.032 |
% |
|
0.000 |
% |
|
0.000 |
% |
拉杰什·古普塔 |
|
|
5,000 |
|
|
0.020 |
% |
|
0.000 |
% |
|
0.000 |
% |
阿尼尔·苏普尔 |
|
|
4,000 |
|
|
0.016 |
% |
|
0.000 |
% |
|
0.000 |
% |
桑吉塔·詹瓦尔 |
|
|
2,400 |
|
|
0.009 |
% |
|
0.000 |
% |
|
0.000 |
% |
Karthikeyan Venkatraman |
|
|
2,000 |
|
|
0.008 |
% |
|
0.000 |
% |
|
0.000 |
% |
Lamitra Praveen Dhir |
|
|
1,800 |
|
|
0.007 |
% |
|
0.000 |
% |
|
0.000 |
% |
Sravanthi Madhadi |
|
|
1,200 |
|
|
0.005 |
% |
|
0.000 |
% |
|
0.000 |
% |
伊隆达有限公司 |
|
|
1,000 |
|
|
0.004 |
% |
|
0.000 |
% |
|
0.000 |
% |
其他公司股东持有的合计 |
|
|
328,400 |
|
|
1.297 |
% |
|
0.000 |
% |
|
0.000 |
% |
|
|
|
|
|
|
|
|
|
|
|
|
|
|
公司普通股总数 |
|
|
25,348,400 |
|
|
100.000 |
% |
|
100.000 |
% |
|
100.000 |
% |
附件一-1
附件二
GIOSTAR供应协议条款
1. |
根据GIOSTAR供应协议,GS将按照以下时间表向公司及其子公司提供GS的干细胞化妆品血清(“血清”): |
交货日期 |
|
总成本 |
|
|
收盘后立即 |
|
$ |
500,000 |
|
在第一个(1St)闭幕周年 |
|
$ |
1,000,000 |
|
在第二个(2nd)闭幕周年 |
|
$ |
2,000,000 |
|
第三次(3rd)闭幕周年 |
|
$ |
4,000,000 |
|
在第四个(4第)闭幕周年 |
|
$ |
6,000,000 |
|
合计 |
|
$ |
13,500,000 |
|
2. |
GS将按GS的每单位直接可变成本(不加价),加上合理的每单位自付费用交付成本(“单位成本”),向公司及其子公司供应血清。GS将尽其商业上合理的努力,将单位成本保持在不超过公司及其子公司能够向第三方(包括根据白标安排)转售此类血清的两(2)倍的水平。在收到血清后,公司及其子公司将获得血清的所有权和损失风险。 |
3. |
根据GIOSTAR供应协议所要求的付款将由买方或本公司全权酌情决定,以(i)现金或(ii)交付新发行的买方A类普通股股份的方式支付,在紧接付款到期日期之前的二十(20)个交易日内,每一此种股份的价值按买方A类普通股的VWAP计算;但在交易结束后的第一笔付款将仅以买方A类普通股的股份支付,每一股的价值按赎回价格计算。除交割时的首期付款外,买方或本公司应在交割后十(10)个工作日内付款;但如果对所欠金额有争议,买方和本公司可扣留善意争议的金额,直至争议解决。任何逾期付款都将加上美国联邦适用利率的利息。 |
4. |
除交割后的初始交货日期外,GS将在适用的交货日期前至少十五(15)个工作日通知买方和本公司拟议的单位成本。如果买方提出要求,GS将在提出要求后尽快(亲自或通过电话会议或视频会议)与买方和本公司会面,讨论拟议的此种装运的单位成本,而双方将尽其善意和合理的努力在此种交货日期之前商定此种装运的单位成本。如果双方不能在交货日期之前就此种货物的单位成本达成协议,则交货日期最多应再推迟三十(30)天,直到双方就单位成本达成协议,并且双方应在此期间继续合理和真诚地谈判单位成本。如果在该三十(30)天期限结束时,双方仍未就该交货日期的单位成本达成协议,则由买方自行决定书面选择,GS应在该交货日期跳过血清的装运,且双方均不应就该交货日期承担任何进一步的义务(但如果买方未作出跳过装运的选择,双方应继续合理和真诚地就该交货日期的单位成本进行谈判)。 |
5. |
GS将按照其目前的产品规格生产血清,除非买方和本公司另有约定,否则将按照所有适用的法律生产,且不低于行业标准。 |
6. |
GS将授予买方、本公司及其各自的子公司在世界任何地方分销和销售血清的独家许可(包括根据白标安排将其转许可给第三方的权利)。 |
7. |
对于与血清的开发、许可、制造或分销有关的任何第三方索赔(由买方、本公司及其各自的子公司分销除外),GS将对买方、本公司及其各自的代表进行赔偿、辩护并使其免受损害。 |
8. |
根据GIOSTAR供应协议,买方无私的独立董事将代表买方和本公司作出一切决定和采取一切行动。 |
9. |
GIOSTAR供应协议可在完成最后一次血清交付之前终止:(a)经双方共同协议;(b)由买方在任何时候出于任何理由或无理由自行选择;或(c)由GS就买方或本公司的重大违约行为在三十(30)天通知期后仍未得到纠正。 |
10. |
GIOSTAR供应协议将受特拉华州管辖法律和纽约市专属管辖权的管辖。 |
附件二-1
形式
JOINDER TO BUSINESS COMBINATION Agreement
本《商业合并协议》(本《合并协议》)由下列签署方于2023年[ __ ]日订立。兹提及日期为2023年3月8日的某些业务合并协议(该协议可能会不时修订或补充,包括由本合并人修订或补充,简称“协议”),由下列各方签署:(i)Apeiron Capital Investment Corp.,一家特拉华州公司(“买方”);(ii)Apeiron Capital Sponsor,LLC,一家特拉华州有限责任公司,在交易结束后担任代表(定义见协议);(iii)GIO World Health,Ltd.,一家根据英格兰和威尔士法律成立的私人公司(“公司”);(iv)Deven Patel,根据协议的条款和条件担任卖方代表(“卖方代表”)和(v)在协议中被指定为卖方的公司股东(包括在协议日期之后加入业务合并协议的股东)(“卖方”)。此处使用的大写术语无需定义,应具有本协议赋予的含义。
证明:
鉴于下列签署人(“加入卖方”)希望根据本合并条款和条件成为本协议的一方,作为本协议下的“卖方”一方。
因此,为了良好和有价值的代价,兹确认其收到和充足,双方在此商定如下:
1.协议受约束。(a)确认加入卖方已收到并审阅本协议的完整副本,包括其附件和附表,以及根据买方就本协议所设想的交易在表格S-4上提交的登记声明向美国证券交易委员会(SEC)提交的最终代理声明/招股说明书(包括其附件);(b)同意在签署本合并声明并将本合并声明交付给买方、公司和代表各方后,加入卖方将成为本协议的一方,并受其完全约束,(c)同意签署并向买方、本公司及代表各方交付根据本协议须由卖方签署的所有附属文件;及(d)同意签署并向买方、本公司及代表各方交付根据本协议须由卖方签署的所有附属文件;及(d)同意本合并文件,包括本第1节的规定及卖方在下文第2节所作的陈述及保证,协议将被视为纳入、补充和成为协议的一部分,协议和协议中对协议的任何提及将包括本合并协议。
2.声明和保证:除联合卖方向买方、本公司和代表各方作为本联合卖方的附件所提交的任何披露时间表中可能规定的情况外(其章节编号与它们所指的协议第五条的章节编号相对应),联合卖方在此向买方声明和保证,本公司及代表各方,本协议第五条所载的陈述及保证于本协议签署之日对加入卖方是真实和正确的,并于截止日期将是真实和正确的。
3.发现者和经纪人。任何经纪人、发现者或投资银行家均无权根据联合卖方或其代表所作的安排,从买方、本公司或其任何关联公司收取与本协议所设想的交易有关的任何经纪、发现者或其他费用或佣金。
4.提供的资料。加入卖方所提供或将提供的任何资料,均未明示列入或以引用方式纳入,最终亦未列入或以引用方式纳入:(i)任何有关表格8-K的现行报告,及其任何证物,或就该合并卖方所设想的交易向任何政府当局(包括证券交易委员会)作出的任何其他报告、表格、登记或其他备案,本协议或任何附属文件;(ii)在登记声明中;或(iii)就本合并协议或本协议所设想的交易的完成向买方股东和/或潜在投资者邮寄或以其他方式分发,或在对第(i)至(iii)条所指明的任何文件的任何修订中,在提交、提供、邮寄或分发(视情况而定)时,将载有任何有关重要事实的不实陈述,或省略说明任何需要在该等陈述中陈述或作出该等陈述所必需的重要事实,根据它们是在什么情况下制造的,而不是误导。尽管有上述规定,Joining Seller并不就买方或其附属公司提供或代表买方或其附属公司提供的任何信息作出任何陈述、保证或契约。
5.独立调查。联合卖方已对买方和公司的业务、经营结果、状况(财务或其他方面)和资产进行了独立调查、审查和分析,并承认已为此目的向其提供了充分的查阅买方和公司的人员、财产、资产、房地、簿册和记录以及其他文件和数据的渠道。加入卖方承认并同意:(i)在决定订立本
加入并成为本协议的一方,并完成本协议所设想的交易,本公司完全依赖其自身的调查以及本协议第三条和第四条(包括披露附表的相关部分)以及根据本协议交付给加入卖方的任何证书中所载的买方和本公司的明确陈述和保证;(ii)买方或本公司或其各自的代表均未就买方或本公司或本合并或本协议作出任何陈述或保证,除非协议(包括披露附表的相关部分)或依据协议交付给加入卖方的任何证书中明确规定。
6.责任。双方同意,在执行本联合协议时,联合卖方仅作为一个实体(而不是其任何非方关联公司),仅应根据本协议和本联合协议的明确条款对双方承担责任。
7.杂项。
a. |
本合并应受特拉华州法律的管辖、解释和执行,而不考虑其中的法律冲突原则。本联合协议、本协议及附属文件,连同本协议所附或本协议所指或本协议所指的其他文件或文书,构成联合卖方就本协议及本协议标的事项所达成的全部协议,并取代联合卖方先前就其标的事项所达成的所有口头和书面协议和谅解。本合并条款应以符合本协议规定的方式加以规范、执行、解释和解释。 |
b. |
由本协定引起的或与本协定有关的所有诉讼,应只在纽约、纽约的任何州或联邦法院(或其任何上诉法院)(“指定法院”)审理和裁定。联合卖方特此(a)就本协议任何一方提出的因本协议而产生或与本协议有关的任何诉讼而言,服从任何指定法院的专属管辖权,并且(b)不可撤销地放弃并同意在任何此类诉讼中不以动议、抗辩或其他方式主张其本人不受上述法院的管辖、其财产被豁免或免于扣押或执行、诉讼是在一个不方便的法院提起的、诉讼地点不适当的任何主张,或本协议或本协议所设想的交易不得在任何指定法院或由任何指定法院强制执行。加入卖方同意,任何诉讼的最终判决应是结论性的,并可在其他法域通过对判决提起诉讼或以法律规定的任何其他方式予以执行。在与本协议所设想的交易有关的任何其他诉讼中,联合卖方不可撤销地同意以其本人或其财产的名义将传票和投诉及任何其他程序送达,方式是亲自将该程序的副本送至联合卖方在本协议签字页上其名称下方所列的适用地址。 |
c. |
放弃审判。本协议、本协议、本协议或本协议所设想的交易直接或间接引起的任何诉讼,本协议、本协议或本协议或本协议所设想的交易,在适用法律允许的最大限度内,本协议的卖方在本协议或本协议允许的范围内,对本协议或本协议所设想的任何诉讼行使本协议或本协议允许的范围内,本协议或本协议允许的范围内,本协议或本协议允许的范围内,本协议或本协议允许的范围内,本协议或本协议允许的范围内,本协议或本协议允许的范围内,本协议或本协议允许的范围内,本协议或本协议允许的范围内,本协议或本协议允许的范围内,本协议或本协议允许的范围内,本协议或本协议允许的范围内,本协议或本协议的范围内,本加入卖方证明,协议的任何其他方的代表均未明确或以其他方式表示,在任何行动的情况下,该其他方不会寻求强制执行上述放弃。 |
d. |
对应部件。本协议可由一个或多个对应方签署和交付(包括通过传真或其他电子传输),也可由本协议的不同缔约方在不同的对应方签署和交付,每一份协议在签署时应被视为原件,但所有这些协议加在一起应构成同一份协议 |
[签名页紧随其后]
作为证明,下列签署人已藉妥为给予的授权,安排由下列签署人或其妥为授权的人员于上述日期签署及交付本合并书。
|
加入卖家: |
|
|
|
|
|
[ |
] |
|
|
|
|
签名: |
|
|
姓名: |
|
|
职位: |
|
公司数目 |
|
拥有的普通股: |
|
通知地址: |
|
地址: |
|
|
|
传真号码: |
|
电话号码: |
|
电子邮件: |
|
确认和接受截至上述第一个日期:
|
购买者: |
|
|
|
|
|
APEIRON CAPITAL INVESTMENT CORP。 |
|
|
|
|
|
|
|
|
签名: |
|
|
姓名: |
|
|
职位: |
|
|
||
|
采购代表: |
|
|
|
|
|
APEIRON CAPITAL SPONSOR LLC |
|
|
|
|
|
签名: |
|
|
姓名: |
|
|
职位: |
|
|
|
|
|
公司: |
|
|
|
|
|
GIO世界健康有限公司。 |
|
|
|
|
|
签名: |
|
|
姓名: |
|
|
职位: |
|
|
|
|
|
卖方代表: |
|
|
|
|
|
|
|
|
|
|
|
||
|
德文·帕特尔 |
|
|
||
[页的其余部分有意留白;签名页如下]
附件A-2
商业合并协议第1号修正案
本企业合并协议第1号修正案(本“第1号修正案”)是由以下各方根据BCA(“买方代表”)的条款和条件作出并于2023年5月10日生效的:(i)特拉华州公司Apeiron Capital Investment Corp.(连同其后继者,即“买方”),(ii)特拉华州有限责任公司Apeiron Capital保荐人有限责任公司,自交易结束之日起至交易结束后,作为买方股东(卖方及其各自的后继者和受让人除外)的代表,(iii)GIO World Health,Ltd.,根据英格兰和威尔士法律成立的私人公司(“公司”),(iv)本协议附件一所列在本协议之日已签署并交付本协议副本的本公司各股东(统称为“签署卖方”),以及(vi)德文·帕特尔(Deven Patel),根据本协议的条款和条件,以卖方代表的身份(“卖方代表”)。本文中使用但未定义的大写术语应具有原《巴塞尔公约》中赋予这些术语的相应含义(定义如下)。
鉴于买方、买方代表、本公司、签署卖方和卖方代表是截至2023年3月8日订立的某些业务合并协议(“原始BCA”)的当事方。
鉴于此,双方希望根据本协议规定的条款和条件(经修订,包括本修正案所称的“BCA”)对原BCA进行修订。
因此,考虑到上述情况以及下文所载的各项陈述、保证、契约和协议,并考虑到其他良好和有价值的代价,兹确认这些代价的收到和充分性,并根据原始BCA的条款,本合同各方打算受法律约束,特此同意如下:
1.国家交易所;交易所。双方在此商定
(a)在原《巴塞尔公约》中出现大写的“National Exchange”一词的每一种情况下,该术语应被视为修改,代之以大写的“Exchange”一词,其含义如下:
“交易所”是指(i)根据《交易法》第6(a)条在SEC注册的任何美国证券交易所,包括纽约证券交易所、纳斯达克、纽约证券交易所美国分公司或任何类似的交易所,或(ii)由OTC Markets Group Inc.运营的交易市场。
(b)原《巴塞尔公约》第7.1(i)条应全部修订和重述如下:
交换清单。买方在收盘后和收盘赎回生效后,应已收到买方和本公司合理可接受的证据,证明买方A类普通股股票应在收盘后立即在国家交易所上市,或在国家交易所上市的情况下,基于上市资格或其他因素,在商业上不合理或不可能(由买方及其法律顾问确定,经与本公司及其法律顾问磋商),交易所。
2.交换考虑。现将原《巴塞尔公约》第1.2节全文修订和重述如下:
1.2交换考虑。在交易结束时,根据本协议的条款和条件,作为所购股份的对价,卖方应有权向其合计发行若干股买方A类普通股(“交易所股份”),其总价值等于(a)250,000,000美元(250,000,000美元),乘以(b)百分比(“所购股份百分比”)等于(i)所购股份总数,除以(ii)公司已发行及未发行股本股份总数加上公司库藏股本股份数目(“交换代价”)。对于卖方在交易结束前持有的每一购买股份,该卖方应获得的交换股份数量等于(A)该卖方的按比例股份除以(B)赎回价格,每一卖方的“按比例股份”将根据该卖方所拥有的购买股份与公司已发行和流通股本总数的百分比加上公司库存股本的数量确定。在交割后立即以库存形式持有的本公司任何股本股份将由本公司注销。
A-2-1
即使本协议另有相反规定,买方将不会凭藉本协议或本协议所设想的交易而发行买方A类普通股的任何零头,而每名本应有权获得买方A类普通股的零碎股份的人(在将买方A类普通股的所有零碎股份合并后,否则将由该人收到),则须将向该人发行的买方A类普通股的股份数目,按总数四舍五入至买方A类普通股最接近的整股。此外,在交割后,在遵守本协议规定的条款和条件的情况下,如果符合第1.3节规定的适用股价目标,收益卖方应有权从买方获得收益股票作为额外对价。为免生疑问,公司证券的持有人将不会根据本协议或与本协议有关而收取任何代价,除非他们是本协议项下的卖方,或作为签署卖方或联合卖方,然后只就他们所拥有的已发行和未发行的公司普通股收取代价。
3.公司资本化。
(a)双方特此同意,现将第4.3(a)条的前两句删除,全部改为:"本公司获授权发行25,328,400股公司普通股,其中23,828,312股已发行和未发行。1,520,088股公司普通股以库存形式持有。”
(b)现将原《巴塞尔公约》附件一全文作为附件一加以修订和重述。
4.公司重组。双方在此商定:
(a)原《巴塞尔公约》第6.20(a)条现予修正和重述,全文如下:
在交割前,本公司应并应促使其关联公司GIOSTAR真诚地谈判本公司与买方之间的供应协议(“GIOSTAR供应协议”),该协议符合本协议附件二中规定的条款,其形式和内容自交割之日起生效,买方可以合理接受。
(b)原《巴塞尔公约》第6.20(b)条现予修正和重述,全文如下:
在本协议的日期后(以及就本协议附表6.20(b)(“公司重组附表”)所描述的任何特定行动或交易而言,在任何该等交易或行动须按照公司重组附表进行或完成的日期或之前),在切实可行范围内尽快进行,目标公司及卖方应完成(而各适用卖方应促使目标公司或该卖方的适用关联公司完成)目标公司及目标公司及卖方各自关联公司的业务重组,如公司重组时间表所述。
(c)现将原《巴塞尔公约》附表6.20(b)全文修订和重述,作为附件二。
(d)原《巴塞尔公约》第7.3(e)条现予修正和重述,全文如下:
本公司及任何目标公司的每一附属公司或任何卖方(视情况而定)均应已完成或促使完成本公司重组,其形式和实质应为买方合理接受。
5.杂项。除本修正案另有明文规定外,《巴塞尔公约》原件及附属文件中的所有条款和规定均保持不变,并在符合其中规定的条款和条件的情况下完全有效。本修正案并不直接或间接构成对原《巴塞尔公约》任何条款或任何附属文件的修正或放弃,也不构成任何一方的任何其他权利、补救办法、权力或特权的修正或放弃,除非在此明确规定。在《巴塞尔公约》或与此有关的任何其他协议、文件、文书或证书中对《巴塞尔公约》的任何提及,以下均指经本修正案修订的《巴塞尔公约》原件(或在本修正案之日后根据其条款对《巴塞尔公约》作进一步修订或修改)。经本修正案修正的《巴塞尔公约》及其所附文件或文书,或在本修正案或其中提及的文件或文书,构成双方就《巴塞尔公约》主题事项达成的全部协议,并取代双方先前就其主题事项达成的所有口头和书面协议和谅解。如果原BCA的任何规定与本修正案的任何规定有实质性的不同或不一致,则应以本修正案的规定为准,而原BCA的规定,只要有此种不同或不一致,应予忽略。本修订的解释、解释、规管及执行方式须与原《巴塞尔公约》相一致,而在不限制上述规定的情况下,原《巴塞尔公约》第10.1至10.12条及第10.13至10.18条为
A-2-2
作为证据,本协议双方自上述日期起已签署本《企业合并协议第1号修正案》。
|
买方: |
|
|
|
|
|
Apeiron Capital Investment Corp. |
|
|
|
|
|
|
|
|
签名: |
Joel Shulman |
|
|
姓名:Joel Shulman |
|
|
职务:首席执行官 |
|
|
|
|
|
|
|
买方代表: |
|
|
|
|
|
Apeiron Capital担保有限责任公司,仅以买方代表的身份 |
|
|
|
|
|
|
|
|
签名: |
Joel Shulman |
|
|
姓名:Joel Shulman |
|
|
头衔:管理成员 |
|
|
|
|
|
|
|
公司: |
|
|
|
|
|
GIO世界健康有限公司。 |
|
|
|
|
|
|
|
|
签名: |
Deven Patel |
|
|
姓名:Deven Patel |
|
|
职务:首席执行官 |
|
|
|
|
|
|
|
卖方代表: |
|
|
|
|
|
|
|
|
Deven Patel |
|
|
Deven Patel,仅以卖方代表的身份 |
|
A-2-4
附件一
本附件一的内容全部修正和取代了原来的《巴塞尔公约》附件一的内容。
附件一
卖方名单
卖方名称 |
所持公司普通股数量 |
占总股份的百分比 |
当前按比例分摊的份额 |
当前收益按比例分摊 |
签署卖方 |
|
|
|
|
全球干细胞治疗研究所和研究公司。 |
17,000,000 |
67.118% |
68.000% |
81.731% |
泰格伙伴有限公司。 |
2,679,912 |
10.581% |
10.720% |
0.000% |
德文·帕特尔 |
1,900,000 |
7.501% |
7.600% |
9.135% |
Anand Srivastava博士 |
1,900,000 |
7.501% |
7.600% |
9.135% |
签署卖方持有的合计 |
23,479,912 |
92.702% |
100.000% |
100.000% |
|
|
|
|
|
其他公司股东 |
|
|
|
|
苏雷什·德奥普拉 |
210,000 |
0.829% |
0.000% |
0.000% |
阿尼尔·阿内亚 |
20,000 |
0.079% |
0.000% |
0.000% |
拉姆·巴赫提 |
20,000 |
0.079% |
0.000% |
0.000% |
杰西·David Mitchell |
20,000 |
0.079% |
0.000% |
0.000% |
尼哈尔·德奥普拉 |
13,000 |
0.051% |
0.000% |
0.000% |
钱德拉普拉卡什·纳姆瓦尔 |
10,000 |
0.039% |
0.000% |
0.000% |
森博·皮莱 |
10,000 |
0.039% |
0.000% |
0.000% |
Priyanka Amreesh Jhanwar |
8,000 |
0.032% |
0.000% |
0.000% |
拉杰什·古普塔 |
5,000 |
0.020% |
0.000% |
0.000% |
阿尼尔·苏普尔 |
4,000 |
0.016% |
0.000% |
0.000% |
桑吉塔·詹瓦尔 |
2,400 |
0.009% |
0.000% |
0.000% |
Karthikeyan Venkatraman |
2,000 |
0.008% |
0.000% |
0.000% |
Lamitra Praveen Dhir |
1,800 |
0.007% |
0.000% |
0.000% |
Sravanthi Madhadi |
1,200 |
0.005% |
0.000% |
0.000% |
伊隆达有限公司 |
1,000 |
0.004% |
0.000% |
0.000% |
其他公司股东持有的合计 |
328,400 |
1.297% |
0.000% |
0.000% |
|
|
|
|
|
库存股份 |
1,520,088 |
6.002% |
0.000% |
0.000% |
|
|
|
|
|
公司普通股总数 |
25,328,400 |
100.000% |
100.000% |
100.000% |
A-2-5
附件D
表格OF GIO WORLD HEALTH HOLDINGS,INC。
2023年股权激励计划
第1节。一般。
GIO World Health Holdings,Inc. 2023股权激励计划(“计划”)的目的是:(a)通过与公司目标一致的短期和长期激励措施,鼓励公司的盈利能力和增长;(b)激励参与者在个人表现方面的卓越表现;(c)促进参与者之间的团队合作;以及(d)让公司在吸引和留住关键员工、董事和顾问方面具有显着优势。为达到上述目的,该计划规定,公司可授予(i)期权、(ii)股票增值权、(iii)限制性股票、(iv)限制性股票单位、(v)其他基于股份的奖励、(vi)其他基于现金的奖励或(vii)上述任何组合。
第2节。定义。
为本计划的目的,下列术语的定义如下:
(a) |
“管理人”指董事会,或在董事会不管理计划的情况下,根据计划第3节的规定,指委员会。 |
(b) |
“关联人”是指通过一个或多个中间人直接或间接地控制或受其控制或与其共同控制的人。就本定义而言,只有在必要的所有权或控制关系得以维持的时期内,一个实体才应被视为本公司的附属公司。就本定义而言,对任何人所使用的“控制”(包括具有相关含义的术语“控制”、“受控制”或“受共同控制”),是指直接或间接拥有权力,以指示或促使指示该人的管理和政策,无论是通过对有表决权的证券的所有权,还是通过合同或其他方式。 |
(c) |
“公司章程”指经修订和/或重述并不时生效的公司注册证书。 |
(d) |
就期权或股票增值权而言,“自动行使日”是指根据本计划第7(i)条规定的期权或根据本计划第8(g)条规定的股票增值权的适用期限的最后一个营业日。 |
(e) |
“奖励”是指根据本计划授予的任何期权、股票增值权、限制性股票、限制性股票、其他基于股票的奖励或其他基于现金的奖励。 |
(f) |
“授标协议”是指一份书面协议、合同或其他文书或文件,证明根据该计划授予的单个授标的条款和条件。裁决的证据可采用书面或电子形式,可限于在公司的簿册及纪录上注明,而经署长批准后,无须由公司代表或参加者签署。根据该计划可交付予参与者的任何股份,可以参与者的名义以证书形式或以参与者的名义以记账式形式发行。每份授标协议应遵守计划的条款和条件。任何授标的潜在接受者对该授标不享有任何权利,除非及直至该接受者已收到授标协议,并如署长在授标协议中要求,在授标日期后六十(60)天内(或署长指明的其他期间)签立并向公司交付一份完整签立的授标副本。 |
(g) |
“受益所有人”(或其任何变体)具有《交易法》第13d-3条中定义的含义。 |
(h) |
“董事会”是指公司的董事会。 |
(一) |
“章程”指经修订和/或重述并不时生效的公司章程。 |
(j) |
在任何公司、子公司或附属公司未到期的雇佣、遣散费或与参与者的类似协议或奖励协议中,或者如果不存在此类协议,或者如果存在此类协议,“原因”应具有赋予该术语的含义 |
D-1
协议中没有定义“原因”(或类似含义的词),“原因”是指(i)参与者违反受托责任或对公司的忠诚义务,(ii)参与者对重罪或涉及道德败坏的罪行的定罪或抗辩,(iii)参与者未能、拒绝或忽视代表公司或公司子公司履行和履行其职责和责任(残疾原因除外),或未能遵守董事会或其指定人员的任何合法指令,(iv)参与者违反公司或其附属公司或附属公司的任何书面政策(包括但不限于与性骚扰或泄露或滥用机密信息有关的政策),(v)参与者违反与公司或其附属公司或附属公司的任何协议(包括但不限于任何保密、不竞争、不邀请或转让发明协议),(vi)参与者对公司或其附属公司或附属公司的业务实施欺诈、不诚实、盗窃、挪用公款、自我交易、挪用公款或其他渎职行为,(vii)参与者在履行其合法职责或责任的任何方面,作出构成重大疏忽或严重失当的作为或不作为,而该等作为或不作为已对公司、其附属公司或附属公司产生或预期会产生不利影响。如果在其雇用终止之日,存在可以证明因因原因而终止雇用的事实和情况,但在此种事实和情况在终止雇用后三(3)个月内被发现的情况下,该参加者的雇用应被视为因“因”而终止。署长应以其绝对酌情决定权,决定所有与参加者是否因事被解职有关的事项和问题的效力。
(k) |
“资本变动”是指任何(i)合并、合并、重新分类、资本重组、分拆、分拆、回购或其他重组或公司交易或事件,(ii)特别股息(无论是以现金、股份或其他财产的形式)、股票分割或反向股票分割,(iii)股票合并或交换,(iv)公司结构的其他变化或(v)支付任何其他分配,在任何此类情况下,管理人全权酌情决定影响普通股,以便根据计划第5节进行调整是适当的。 |
(l) |
“控制权变更”是指发生以下任何一种情况: |
(一) |
任何人(本公司或其附属公司除外)直接或间接成为本公司证券的实益拥有人,代表本公司当时已发行的有表决权证券(“已发行的有表决权证券”)的总投票权的百分之五十(50%)以上,但不包括因以下第(iii)款(A)款所述的交易或直接从本公司取得的任何收购而成为该实益拥有人的人;或 |
(二) |
下列个人因任何原因不再构成当时在董事会任职的董事人数的多数:在连续两(2)年的任何期间内组成董事会的个人和任何新的董事(但最初就职与实际或可能的选举竞争有关的董事除外,包括但不限于征求同意,与公司董事的选举有关)其委任或由董事会选举或由公司股东选举的提名经至少三分之二的表决通过或推荐(2/3)在两(2)年期间开始时为董事或其委任、选举或选举提名先前已获如此批准或推荐的当时仍在任的董事;或 |
(三) |
完成本公司或其任何附属公司与任何其他公司的合并或合并,但合并或合并(A)除外,该合并或合并导致紧接其之前的未偿付公司表决权证券继续代表(通过剩余未偿付或转换为存续实体的有表决权证券)在紧接该合并或合并后未偿付的未偿付公司表决权证券(或该存续实体,或者,如果该公司或该合并后的存续实体当时是子公司,则为其最终母公司)的合并表决权的至少百分之五十(50%),(B)紧接其后,紧接其后组成紧接其后的董事会的个人,至少构成该合并或合并后存续实体的董事会的多数,或如该公司或该合并后存续实体当时是附属公司,则构成该合并或合并后存续实体的最终母公司;或 |
(四) |
公司的全部清算或解散计划的完成,或公司出售或处置公司全部或基本全部资产的协议的完成,但(A)公司将公司全部或基本全部资产出售或处置给一个实体的情况除外,其有表决权的证券的总投票权的至少百分之五十(50%)为 |
D-2
在该交易完成后由公司股东直接或间接拥有,其比例与其在紧接该出售之前对公司的所有权基本相同,或(B)出售或处置公司的全部或几乎全部资产,在紧接其后组成董事会的个人至少在出售或处置该资产的实体的董事会中占多数,如果该实体是其子公司,则构成该实体的最终母公司。
对于根据《守则》第409A条构成递延补偿的每项裁决,只有在公司所有权或有效控制权的变更或公司大部分资产所有权的变更也构成《守则》第409A条规定的“控制权变更事件”的情况下,控制权变更(如适用)才应被视为根据本计划就该裁决发生。
(m) |
“控制价格的变化”应具有计划第13节中规定的含义。 |
(n) |
“法典”是指不时修订的1986年《国内税收法》或其任何后续版本。凡提述守则的某一节,即视为包括提述根据守则颁布的任何条例。 |
(o) |
“委员会”是指董事会任命的负责管理该计划的任何委员会或小组委员会。在董事会酌情决定的情况下,委员会应完全由符合《交易法》第16b-3条所指的“非雇员董事”资格以及股票交易的适用证券交易所所要求的任何其他资格的个人组成。如果管理局在任何时候或在任何程度上不管理计划,则计划中指定的署长的职能应由委员会行使。除公司的法团章程或附例另有规定外,委员会就本计划的管理而采取的任何行动,须在会议上以过半数票作出,而会议的法定人数已妥为组成,或委员会成员以书面一致同意的方式作出。 |
(p) |
“普通股”是指公司的普通股,每股面值0.0001美元(以及这些普通股可以转换成或交换成的任何股票或其他证券)。 |
(q) |
“公司”指的是GIO World Health Holdings,Inc.,一家特拉华州公司(或任何继承公司,但上文“控制权变更”定义中使用的“公司”一词除外)。 |
(r) |
“顾问”指作为独立承包商向本公司或其附属公司提供真诚服务的任何现有或未来的顾问或独立承包商,并根据《证券法》S-8表格A.1(a)(1)的指示,符合顾问或顾问的资格。 |
(s) |
“董事”是指在生效日期当日或之后成为董事会成员的任何个人。 |
(t) |
“残疾”是指《守则》第22(e)(3)节所述的永久和完全残疾的任何参与者。 |
(u)“生效日期”应具有《计划》第24节所述的含义。
(u) |
就根据本计划发行的以普通股计价的奖励而言,“合资格受助人”指:(i)雇员;(ii)非雇员董事;或(iii)在每种情况下,均由管理人选定为本计划下的合资格受助人的顾问;但在合资格受助人首次为本公司或其附属公司提供服务的日期之前授予的任何奖励将不会被授予或行使,且不得就该等奖励向该等合资格受助人发行股份或支付其他款项,在该合格受益人首次为本公司或其附属公司提供服务的日期之前。尽管有上述规定,在避免根据《守则》第409A条征收额外税款所需的范围内,“合格受益人”是指:(1)雇员;(2)非雇员董事;或(3)公司或其附属公司的顾问,在每种情况下,他们已被署长选为该计划下的合格受益人。 |
(五) |
“雇员”是指公司或其子公司的任何现任或未来雇员,包括同时被视为雇员的执行官或董事。 |
(w) |
“交易法”指的是不时修订的1934年《证券交易法》。 |
D-3
(十) |
“执行人员”是指作为公司执行人员(根据《交易法》第3b-7条的含义)的每一位参与者。 |
(y) |
“行使价”是指,就持有人可购买股份的任何奖励而言,根据本协议授予的此类奖励的持有人可购买在行使此类奖励时可发行的股份的每股价格,由管理人根据适用的《守则》第409A条确定。 |
(z) |
“公允市场价值”是指某一特定日期的股票价值,按如下方式确定: |
(一) |
如果股票在已建立的证券市场上易于交易,则公允市场价值应为股票在确定当日在该证券市场上所报的收盘价(如果没有销售报告,则为紧接该日期之前日期的收盘价); |
(二) |
如果股票当时不能在一个成熟的证券市场上随时交易,但由一家公认的证券交易商定期报价,但没有报告卖出价格,则公允市场价值将是根据美国证券交易商协会的报告,在确定当日股票的高出价和低要价之间的平均值。自动报价系统是在该市场上出售股票的前一个日期;或者 |
(三) |
如果股票不能在已建立的证券市场上随时交易,则公允市场价值将由管理人真诚地确定。 |
尽管有上述规定,但为了联邦、州和地方所得税报告的目的,以及为了署长认为适当的其他目的,公平市场价值应由署长根据其不时采用的统一和非歧视性标准确定。此外,在所有情况下,公平市场价值的确定应符合《规则》第409A条规定的要求,但以裁决符合或豁免《规则》第409A条为限。署长的决定应是决定性的,并对所有人具有约束力。
(aa) |
“自由权利”应具有该计划第8(a)节所述的含义。 |
(bb) |
“激励股票期权”是指根据《守则》第422条的规定,由管理人指定为激励股票期权的期权,该期权符合本计划的规定。 |
(cc) |
“非雇员董事”是指不是雇员的董事。 |
(dd) |
“非合格股票期权”是指根据其条款不符合激励股票期权条件或不符合激励股票期权条件的股票期权。 |
(ee) |
“期权”是指购买根据该计划第7条授予的股票的期权。 |
(ff) |
“其他现金奖励”是指根据该计划第11条授予参与者的现金奖励,包括作为奖金或在达到绩效目标或完成一段时间的持续雇佣或该计划允许的其他条款或条件时授予的现金。 |
(gg) |
“其他基于股份的奖励”是指根据计划第11条授予参与者的权利或其他权益,可参照或以其他方式基于股份或与股份相关的股份进行计价或支付、全部或部分估值,包括但不限于非限制性股份或股息等价物,每一项都可能受制于业绩目标的实现、持续受雇的时间或计划允许的其他条款或条件。 |
(hh) |
“参与人”是指管理人根据计划第3节规定的管理人权力选定的根据计划获得奖励的任何合格受赠人,以及在其去世后,其继承人、继承人、遗嘱执行人和管理人(视情况而定)仅就在该合格受赠人去世之日尚未获得的任何奖励而选择的任何合格受赠人。 |
(二) |
“业绩目标”是指以署长选定的业绩标准为基础的业绩目标,其中可包括但不限于下列任何一项:(一)息税前利润;(二)息税前利润, |
D-4
税、折旧和摊销;(iii)税后净营业利润;(iv)现金流;(v)收入;(vi)净收入;(vii)销售额;(viii)未完成销售天数;(ix)收入;(x)净收入;(xi)营业收入;(xii)净营业收入;(xii)营业利润率;(xiv)收益;(xv)每股收益;(xvi)股本回报率;(xvii)投资回报率;(xviii)资本回报率;(xix)资产回报率;(xx)净资产回报率;(xxi)股东总回报;(xxii)经济利润;(xxiii)市场份额;(xxiv)公允市场价值的增值,股份的帐面价值或其他价值计量;(xxv)费用或成本控制;(xxvi)营运资金;(xxvii)客户满意度;(xxviii)员工留任或员工更替;(xxx)员工满意度或敬业度;(xxx)环境、健康或其他安全目标;(xxxi)个人表现;(xxxii)战略目标里程碑;(xxxiii)署长全权酌情指定的任何其他标准;及(xxxiv)上述任何标准的任何组合(如适用)。在适用的情况下,业绩目标可以用达到特定标准的特定水平或达到特定标准的百分比增减来表示,可以适用于公司的一个或多个或其子公司或附属公司,或公司的一个部门或战略业务单位,也可以适用于公司相对于市场指数、一组其他公司或其组合的业绩,所有这些都由管理人决定。业绩目标可包括一个最低业绩水平,低于该水平不得付款(或不得归属),应支付特定款项(或发生特定归属)的业绩水平,以及不得支付额外款项(或应全部归属)的最高业绩水平。在授予这一奖项时,署长可具体说明其所使用的业绩目标的任何合理定义。此类定义可规定对业绩目标进行公平调整,以确认因应适用法律或法规的变化而影响公司或其附属公司或附属公司或附属公司的不寻常或非经常性事件或公司或附属公司的财务报表,或对被确定为性质不寻常、不经常发生或性质不寻常以及不经常发生或与处置某部分业务有关或与会计原则变化有关的收益、损失或费用项目进行会计处理。如果署长确定公司的业务、运作、公司结构或资本结构或公司或附属公司开展业务的方式发生变化,或其他事件或情况使业绩目标不适合,署长可酌情对业绩目标进行全部或部分修改。如果参加者在某一执行期间得到晋升、降职或调往不同的业务单位或职能,署长可确定业绩目标或执行期间不再适当,并可(x)酌情调整、更改或取消业绩目标或适用的执行期间,使这些目标和期间与最初的目标和期间相比较,或(y)按署长确定的数额向参加者支付现金。
(jj) |
“人”应具有《交易法》第3(a)(9)条赋予的含义,并在第13(d)和14(d)条中进行了修改和使用,但是,一个人不应包括(i)公司或其任何子公司;(ii)根据公司或其任何子公司的雇员福利计划持有证券的受托人或其他受托人;(iii)根据此类证券的发行暂时持有证券的承销商;或(iv)由公司股东直接或间接拥有的公司,其比例与其持有公司股票的比例基本相同。 |
(kk) |
“计划”是指GIO World Health Holdings,Inc. 2023股权激励计划,该计划经不时修订和/或修订和重述。 |
(ll) |
“相关权利”应具有计划第8(a)节所述的含义。 |
(mm)“受限制股份”是指根据本计划第9条授予的股份奖励,但须受某些限制,而这些限制在一个或多个指定期间结束时失效。
(nn) |
“限制性股票”指根据本计划第10节所述授予参与者的奖励而设立的名义账户,该账户(i)仅参照股份估值,(ii)受奖励协议规定的限制,以及(iii)以现金或股份(如奖励协议规定)支付。授予参与者的限制性股票单位将根据基于时间的标准或业绩目标归属,已归属的限制性股票单位将在授予协议规定的时间结算。 |
(oo) |
“限制期”是指由管理人确定的一段时间,在此期间某一奖项或其部分受到限制,或在适用的情况下,为确定是否已获得该奖项而衡量绩效的一段时间。 |
D-5
(pp) |
“规则16b-3”应具有计划第3(a)节所述的含义。 |
(季度) |
“证券法”指的是不时修订的1933年《证券法》。 |
(rr) |
“股份”指的是一股普通股。 |
(ss) |
“股票增值权”是指根据本计划第8条授予的奖励,有权获得的金额等于(i)在该奖励或其部分被放弃之日的合计公平市场价值超过(ii)该奖励或其部分的合计行使价的部分。 |
(tt) |
就任何人而言,“附属”指在任何确定日期,该第一人拥有或以其他方式直接或间接控制该另一人超过百分之五十(50%)的有表决权股份或其他类似权益,或该另一人的唯一普通合伙人权益或管理成员权益或类似权益的任何其他人。为本定义的目的,一个实体只有在必要的所有权或控制关系得以维持的时期内,才应被视为本公司的子公司。尽管有上述规定,就激励股票期权或与激励股票期权有关的任何决定而言,“子公司”是指属于《守则》第424(f)条所指公司的子公司。 |
(uu) |
“替代奖励”是指公司或其他实体在与公司交易(如合并、合并、合并或收购财产或股票)相关的情况下,在承担或替代未偿股权奖励的情况下,根据本计划授予的奖励;但在任何情况下,“替代奖励”一词都不应被解释为指与期权或股票增值权的取消和重新定价相关的奖励。 |
第3节。行政。
(a) |
该计划应在适用范围内由署长按照《交易法》第16b-3条(“第16b-3条”)的要求管理。 |
(b) |
根据《计划》的规定,署长在任何委员会的情况下,在不受管理局授予的权力的任何限制的情况下,有权不受限制地: |
(一) |
选出符合资格的受助人,他们将成为参加者; |
(二) |
决定是否以及在何种程度上根据本协议向参与者授予期权、股票增值权、限制性股票、限制性股票单位、其他基于股票的奖励、其他基于现金的奖励或上述任何一项的组合; |
(三) |
决定根据每份奖励作出的股份数目; |
(四) |
决定根据本计划所授出的每项奖励的条款及条件,包括但不限于:(A)适用于奖励的限制及适用于该等奖励的限制失效的条件;(B)适用于奖励的表现目标及表现期间(如有的话);(C)每项奖励的行使价;(D)适用于每项奖励的归属时间表;(E)适用于奖励的任何保密或限制性契约条文;及(F)在符合守则第409A条(在适用范围内)的规定下,对未偿奖励条款及条件的任何修订,包括但不限于延长该等奖励的行使期限及加快该等奖励的归属时间表; |
(五) |
确定不与本计划条款相抵触的条款和条件,该条款和条件适用于根据本计划授予的期权、股票增值权、限制性股票、限制性股票单位、其他基于股份的奖励、其他基于现金的奖励或上述任何组合的所有奖励协议; |
(六) |
确定公平市场价值; |
D-6
(七) |
就根据本计划批出的奖助金而言,厘定可批给参加者但不构成终止该参加者的雇用的休假的期限及用途; |
(八) |
决定离开、从全职工作变为非全职工作、部分残疾或参与者的就业状况或服务的其他变化如何(以及是否)影响奖励的归属或终止; |
(九) |
通过、修改和废除其不时认为可取的管理计划的行政规则、准则和做法; |
(十) |
协调本计划、与本计划有关的任何授标协议或其他文书或协议或根据本计划授予的任何授标中的任何不一致之处、纠正其任何缺陷及/或提供其任何遗漏;及 |
(十一) |
解释及解释该计划的条款及条文,以及根据该计划发出的任何授标(及与该计划有关的任何授标协议),并以其他方式监督该计划的管理,并行使根据该计划特别授予的或在管理该计划时所必需及可取的一切权力及权限。 |
(c) |
除适用法律禁止的范围外,署长可将本计划的日常管理以及本计划赋予的任何职能委托给一名或多名个人。此种授权可随时撤销。此种代表的行为应视为署长的行为,此种代表应定期向署长报告所下放的职责和责任以及授予的任何裁决。 |
(d) |
署长根据该计划的规定作出的所有决定均为最终的、结论性的,并对包括公司和参与者在内的所有人具有约束力。管理局或委员会的任何成员,或公司或其任何附属公司代表管理局或委员会行事的任何高级人员或雇员,均无须对就本计划真诚地采取或作出的任何作为、不作为、裁定或解释负个人法律责任,而管理局或委员会的所有成员,以及代表他们行事的公司及其任何附属公司的每名高级人员或雇员,均须在法律准许的最大限度内,获公司就任何该等作为、不作为、裁定或解释作出充分弥偿及保障。 |
第4节。根据该计划和对奖励的限制保留发行的股份。
(a) |
在根据《计划》第5节进行调整的情况下,署长有权就根据《计划》授予的赔偿金提供总额为[ • ]1股份;条件是,根据该计划将保留和可能发行的股份总数将在每个日历年的第一个交易日自动增加,从2024日历年开始,到2033日历年结束,增加的股份数量相当于上一个日历年最后一天已发行和未发行的股份总数的_____%([ •]%)。尽管有上述规定,署长仍可在某一年的1月1日前采取行动,规定该年度的股份储备不会增加,或该年度的股份储备增加的股份数目将少于本条例所规定的数目。 |
(b) |
尽管本文另有相反规定,任何非雇员董事在任何财政年度内所获授予的受奖股份的最高数目,连同在该财政年度内就其作为非雇员董事的服务而支付予该非雇员董事的任何现金费用,不得超过$ 500,000(为财务报告的目的,根据该等奖励的授予日期公平市场价值计算该等奖励的价值)。 |
1买方A类普通股在收盘后立即发行和流通的股份总数的10%(使收盘赎回生效)。
D-7
(c) |
根据本计划发行的股份,可全部或部分为获授权但未获发行的股份,或公司已在或可能在公开市场、私人交易或其他方式重新取得的股份。任何根据本计划获授予的股份,如在生效日期后被没收、取消、结算或以其他方式终止而未向参与者分配股份,其后将被视为可获授予。在适用前一句时,如果(i)以其他方式就任何奖励发行或作为其一部分发行的股份被扣缴以支付税款或任何适用的行使价,则该等股份应被视为已根据本计划发行,不得根据本计划发行;(ii)任何以股份结算的股票增值权或期权被行使,受该等股票增值权或期权约束的股份总数应被视为根据本计划发行,不得根据本计划发行。此外,为行使未行使的期权或其他奖励而投标的股份(x),(y)为支付任何奖励的适用税款而预扣的股份,或(z)使用行使价收益在公开市场上回购的股份,不得根据本计划发行。为免生疑问,(A)须达到业绩目标的奖励所依据的股份,须根据该等奖励的目标值,计入股份储备金,除非及直至该等奖励归属并以股份结算为止;及(B)根据其条款,只可以现金结算的奖励,不得计入本计划第4(a)条所列的股份储备金。 |
| (d) | 替代奖励不应减少根据本计划授权授予的股份。如本公司或其任何附属公司所收购的公司,或本公司或其任何附属公司与其合并的公司,根据经股东批准的预先存在的计划有股份可供使用,但在考虑该收购或合并时未获采纳,则根据该预先存在的计划的条款可供授予的股份(在适当范围内经调整,使用在此种收购或合并中使用的交换比率或其他调整或估值比率或公式来确定支付给此种收购或合并的一方实体的普通股持有人的对价)可用于本计划下的奖励,不得减少根据本计划授权授予的股份;提供则使用该等可供使用的股份作出的奖励,不得在根据先前存在的计划的条款本可作出奖励或授予的日期后作出,而该日期并不包括该项收购或合并,而只应向在该项收购或合并之前没有受雇于本公司或其任何附属公司或向其提供服务的个人作出。 |
(e) |
如果公司或其附属公司完成了《守则》第424(a)条所述的交易(例如,从不相关的公司购买财产或股票),因该交易而成为雇员或董事的人可被授予替代奖励,以取代其前雇主授予的奖励,但任何此类替代期权或股票增值权可被授予,其行使价低于股票在授予日的公平市场价值;但前提是,授予这种替代期权或股票增值权不构成《守则》第424(h)(3)条和适用的财政部条例所定义的“修改”。 |
第5节。公平调整。
(a) |
在资本结构发生任何变化,包括但不限于控制权发生变化的情况下,在每种情况下,均应作出衡平法替代或比例调整,由管理人全权酌情决定:(一)根据本计划保留发行的股份总数;(二)根据本计划授予的未行使期权和股票增值权的种类、数量和行使价格;但期权和股票增值权的任何此类替代或调整应按照《守则》第409A条的要求进行,及(iii)根据计划授予的受限制股份、受限制股份单位或其他以股份为基础的奖励的股份的种类、数目及购买价格(在每种情况下由管理人全权酌情决定),但因调整而产生的任何零碎股份应予消除。其他衡平法上的替代或调整应由署长自行决定。 |
(b) |
在不限制本第5条上述条文的一般性的原则下,对于资本化的变更,署长可全权酌情订定取消根据本条例(i)批出的任何未偿付的授标,以换取以现金或其他财产支付的款项,而该等股份的合计公平市价,如有的话,则以该等股份的合计行使价或购买价(如有的话)为减价,及(ii)就任何行使价或每股购买价高于或等于当时每股公平市价的奖励而言,无须作代价。 |
D-8
(c) |
尽管本计划中有任何相反的规定,但因本第5条所述的调整或替代而对激励股票期权作出的任何调整均应符合《守则》第424(a)条的规定,在任何情况下,不得作出任何调整,使根据本计划授予的激励股票期权不符合《守则》第422条规定的激励股票期权的条件。署长根据本第5节作出的决定应是最终的、有约束力的和结论性的。 |
第6节。资格。
计划下的参与者应由署长自行决定不时从合格受惠人中挑选。
第7节。选项。
(a) |
一般。署长可全权酌情给予参与人选择权。仅就雇员参与者而言,管理人可授予激励股票期权、非合格股票期权或两者的组合。对于所有其他参与者,管理人只能授予不合格的股票期权。获授予期权的每名参与者应与公司订立一份授标协议,其中载有由管理人自行决定的条款和条件,其中应指明该期权是激励股票期权还是不合格股票期权,并应载明(其中包括)期权的行使价格、期权的期限以及关于根据该协议授予的期权的可行使性的规定。每个备选办法的规定不必对每个参加者都是相同的。同一参与者可同时获得一个以上的选择权,但在此项下仍未行使。根据本计划批出的备选办法,须受本第7条所列条款和条件的规限,并须载有署长认为适当并在适用的授标协议内所列的附加条款和条件,但不得与本计划的条款相抵触。 |
(b) |
激励股票期权的限制。如果管理人授予激励股票期权,则在任何个人在任何日历年度(根据公司及其子公司的所有计划)可首次行使激励股票期权的股票的合计公允市场价值超过100,000美元的情况下,根据《守则》第422条的要求,此类期权将被视为非合格股票期权。在不违反《计划》第5节的情况下,可根据拟作为激励股票期权的期权发行的股票的最大数量为[ • ]2股份及为免生疑问,该等股份限额不受本计划第4(a)条所规定的年度调整所规限。 |
(c) |
行使价。行权价格应在授予时由管理人自行决定;但条件是(i)在任何情况下,行权价格不得低于授予日股票公允市场价值的百分之百(100%),以及(ii)授予公司百分之十(10%)股东的激励股票期权(在《守则》第422(b)(6)条的含义内)的行权价格不得低于当日股票公允市场价值的百分之百(110%)。 |
(d) |
选择期限。每份期权的最长期限应由管理人确定,但在任何情况下,不得(i)一份期权可在该期权被授予之日起十(10)年以上行使,以及(ii)一份授予公司百分之十(10%)股东的激励股票期权(根据《守则》第422(b)(6)条的含义)可在该期权被授予之日起五(5)年以上行使。根据《计划》和《授标协议》中的适用条款,每份期权的期限可提前到期。尽管有上述规定,署长仍有权在署长全权酌情认为适当的时间和情况下加速行使任何尚未行使的选择权。尽管本计划(包括但不限于本计划第7(h)节)中有任何相反的规定,但如果在未行使期权到期之日,行使期权,包括以“净行使”或“无现金”方式行使,将违反适用的证券法或公司不时维持的任何内幕交易政策,则适用于该期权的到期日将被延长,除非这种延长将违反《守则》第409A条,期权的行使将不再违反适用的证券法或任何此类内幕交易政策之日后三十(30)天。 |
2等于根据该计划最初保留供发行的股份数目。
D-9
(e) |
可锻炼性。每一备选办法均应在适用的授标协议中规定的时间和条件下行使,包括达到署长应确定的预先设定的业绩目标。署长亦可规定任何选择权只可分期行使,署长可随时根据署长自行决定的因素,全部或部分放弃分期行使的规定。尽管有任何与此相反的规定,期权不能被行使的零头股份。 |
(f) |
锻炼方法。期权可全部或部分行使,方法是向公司发出书面行使通知,指明拟购买的股份数目,同时全额支付由管理人决定的以现金或等值方式购买的股份的合计行使价。就任何期权或任何类别的期权,由署长全权酌情决定,也可(i)以根据署长批准的任何无现金行使程序收取的代价(包括扣留在行使时以其他方式可发行的股份)的方式支付全部或部分款项,(ii)以参与者已拥有的非限制性股份的形式支付,这些股份在放弃之日的公平市场价值等于行使该期权的合计行使价格,(iii)署长批准并获适用法律准许的任何其他形式的考虑,或(iv)上述各项的任何组合。在决定参与者可采用何种方法支付行权价时,管理人可考虑其认为适当的因素;但就奖励股票期权而言,所有此类酌情决定应由管理人在授予时作出,并在授标协议中予以规定。 |
(g) |
作为股东的权利。在参与者就行使期权的股份发出书面通知、全额支付该等股份的款项并符合本计划第17条的规定之前,参与者不得就该等股份享有股息权或股东的任何其他权利。 |
(h) |
终止雇用或服务。除非适用的授标协议另有规定,如任何参与者在本公司及其所有附属公司的雇用或服务终止,则应适用以下条款和条件: |
(一) |
如公司或附属公司无故终止或因任何理由而终止参与者的雇用或服务,或由于该参与者辞职,(A)授予该参与者的选择权,在终止时可行使的范围内,应一直可行使至终止后九十(90)天的日期(如该参与者在该九十(90)天期间死亡,则该期限延长至终止日期后一(1)年),该日期届满,(B)授予该参与人的选择权,在终止时不可行使的范围内,应在终止之日营业结束时失效。尽管有上述规定,任何选择权在其期限届满后均不得行使。 |
(二) |
如参加者因残疾或死亡而终止其雇用或服务,(A)给予该参加者的选择权在终止时可行使的范围内,应继续可行使至终止后一(1)年的日期,在该日期届满;(B)给予该参加者的选择权在终止时不可行使的范围内,应在终止之日营业结束时届满。尽管有上述规定,任何选择权在其期限届满后均不得行使。 |
(三) |
如因事终止参加者的雇用或服务,给予该参加者的所有尚未行使的选择权应在业务开始时于终止之日失效。 |
(四) |
为确定在为本条第7(h)款的目的终止雇用或服务时可行使哪些选择权,仅因禁用期而不能行使的选择权应视为可行使。 |
(五) |
尽管本文另有相反规定,激励股票期权不得在参与者因死亡或残疾以外的任何原因不再是雇员之日起三(3)个月内行使。如果在参与者因死亡或残疾以外的任何原因而不再是雇员之日起三(3)个月后可行使期权,则在这三(3)个月后,该期权应被视为不合格股票期权。 |
D-10
(一) |
自动练习。除非署长在授标协议中另有规定或另有规定,或如参与人以书面向公司作出指示,否则在自动行使日尚未行使的每份既得及可行使期权,其行使价低于在该日期的每股公平市价,均须在自动行使日自动行使,而无须参与人或公司采取进一步行动。由署长全权酌情决定,任何该等期权的行使价须依据本计划第7(f)(i)或(ii)条支付,而公司或任何附属公司或附属公司须根据本计划第17条扣除或扣缴足以支付与该等行使有关的所有税项的款额。除非署长另有决定,否则第7(i)条不适用于在自动行使日期当日或之前参与者的雇用或服务已终止的选择。为免生疑问,任何行使价等于或高于自动行使日每股公平市价的期权,均不得依据第7(i)条行使。 |
第8节。股票增值权。
(a) |
一般。股票增值权可以单独授予(“自由权”),也可以与根据本计划授予的全部或部分期权(“相关权利”)一起授予。与不合格股票期权有关的任何相关权利可在期权授予的同时或在期权授予之后的任何时间授予,但在期权行使或到期之前。与激励股票期权相关的任何相关权利必须在激励股票期权授予的同时授予。获授予股票增值权的每一名参与者应与公司订立一份授标协议,其中载有由管理人自行决定的条款和条件,其中包括行权价、股票增值权的期限以及根据该协议授予的股票增值权的可行权性等条款。尽管有上述规定,任何相关权利的授予不得超过其所涉及的期权所规定的数量,而任何股票增值权的授予价格必须不低于授予日股票的公平市场价值。股票增值权的规定不必对每个参与者都是相同的。同一参与者可同时获得一项以上的股票增值权奖励。根据本计划所批出的股票增值权,须受本条第8款所列的下列条款和条件的规限,并须载有署长认为适当的附加条款和条件,如适用的授标协议所列,不得与本计划的条款相抵触。 |
(b) |
学期。每份股票增值权的最长期限应由管理人确定,但在任何情况下,不得(i)股票增值权可在股票增值权授予之日起十(10)年以上行使,以及(ii)与授予公司百分之十(10%)股东的激励股票期权有关的任何相关权利(根据《守则》第422(b)(6)条的含义)可在股票增值权授予之日起五(5)年以上行使。根据计划和授标协议中的适用条款,每份股票增值权的期限可提前到期。尽管如此,署长仍有权在署长认为适当的时间和情况下,加速行使任何尚未行使的股票增值权。尽管本计划(包括但不限于本计划第8(g)节)中有任何相反的规定,但如果在未行使的股票增值权到期之日,行使股票增值权将违反适用的证券法或公司不时维持的任何内幕交易政策,则适用于股票增值权的到期日将被延长,除非该延长将违反《守则》第409A条,股票增值权的行使将不再违反适用的证券法或任何此类内幕交易政策之日后三十(30)天。 |
(c) |
可锻炼性。 |
(一) |
股票增值权属于自由权,可在管理人在适用的授标协议中确定的时间和条件下行使,包括达到预先设定的业绩目标。 |
(二) |
作为相关权利的股票增值权,只能在与之相关的期权可以按照计划第7节和本第8节的规定行使的时间和范围内行使。 |
D-11
(三) |
管理人还可规定,任何股票增值权只能分期行使,而管理人可随时根据管理人自行决定的因素,全部或部分放弃分期行使的规定。尽管有任何与此相反的规定,股票增值权不能为股票的一小部分行使。 |
(d) |
锻炼方法。股票增值权可以全部或部分行使,方式是向公司发出书面行使通知,指明将购买的股票数量。 |
(e) |
行使时付款。 |
(一) |
在行使自由权时,参与者有权获得最多但不超过该数目的股份,该数目是以公平市价确定的,其价值等于行使当日每股公平市价超过自由权规定的行使价的部分乘以正在行使自由权的股份数目。 |
(二) |
参与人可以通过放弃相关选择权的适用部分来行使相关权利。在行使和放弃时,参与者有权获得最多但不超过使用公平市场价值确定的股份数量,其价值等于行使之日的每股公平市场价值超过相关期权规定的行使价格的部分乘以正在行使相关权利的股份数量。已全部或部分如此放弃的选择权,在相关权利已如此行使的范围内,将不再可行使。 |
(三) |
尽管有上述规定,管理人仍可决定以现金(或股票与现金的任何组合)结算股票增值权的行使。 |
(f) |
终止雇用或服务。 |
(一) |
除本计划第8(b)条另有规定外,如获授予一项或多于一项自由常备权利的参与者终止在本公司及其所有附属公司的雇用或服务,则该等权利可在署长在适用的授标协议中所厘定的时间及条件下行使。 |
(二) |
除本计划第8(b)条另有规定外,如获授予一项或多于一项相关权利的参与者终止在本公司及其所有附属公司的雇用或服务,则该等权利可在有关选择所载的时间及条款及条件下行使。 |
(g) |
自动练习。除非署长在授标协议中另有规定或另有规定,或如参与人以书面向公司作出指示,否则在自动行使日尚未行使的、行使价格低于当日每股公平市价的每一份既得及可行使的股票增值权,均须在自动行使日自动行使,而无须参与人或公司采取进一步行动。本公司或其任何附属公司或附属公司应根据本计划第17条扣除或扣缴足以支付与此项业务有关的所有税款的款项。除非署长另有决定,否则第8(g)条不适用于在自动行使日期当日或之前参与者的雇用或服务已终止的股票增值权。为免生疑问,任何行使价等于或高于自动行使日每股公平市价的股票增值权,均不得依据第8(g)条行使。 |
(h) |
作为股东的权利。被授予股票增值权的参与者,在授予或行使股票增值权方面,不享有作为公司股东的权利。 |
第9节。限制性股票。
(a) |
一般。受限制股份可以单独发行,也可以在根据该计划授予的其他奖励之外发行。获授予受限制股份的每名参与者须与公司订立一份授标协议,其中载有 |
D-12
由管理人全权酌情决定的条款和条件,其中应规定授予的股份数量、参与者为获得限制性股票而支付的价格(如有)、适用于限制性股票的限制期(如有)、适用于限制性股票的业绩目标(如有)以及限制性股票的所有其他条件。如果未达到管理人规定的限制、业绩目标和/或条件,参与者应按照授予条款放弃其限制性股票。每一份限制性股票奖励的规定对每一位参与者来说不一定是相同的。根据本协议,同一参与者可同时获得一项以上的限制性股票奖励。根据本计划批出的受限制股份,须受本第9条所列的条款及条件所规限,并须载有署长认为适当并在适用的授标协议内所列的附加条款及条件,但不得与本计划的条款抵触。
(b) |
证书。除本文另有规定外,(i)每名获授予受限制股份奖励的参与者,可由公司全权酌情就该等受限制股份获发一份股票证书;及(ii)如此发出的任何该等证书,须以该参与者的名义登记,并须附有一个适当的图例,提述适用于该等奖励的条款、条件及限制。公司可规定,证明根据本协议批出的受限制股份的股票证书(如有的话)须由公司保管,直至其限制失效为止,而作为任何授予受限制股份的条件,参与者须已交付与该授予所涵盖的股份有关的空白背书的股票权力。尽管计划中有任何相反的规定,任何受限制股份(不论在任何归属条件已获满足之前或之后),可根据以该等形式发行股份的惯常安排,由公司全权酌情以非凭证式形式发行。 |
(c) |
限制和条件。根据本条第9款批出的受限制股份,须受下列限制和条件以及署长在批出时或其后所决定的任何附加限制或条件的规限: |
(一) |
受限制股份须受授标协议及计划所载的可转让性限制所规限。 |
(二) |
署长可全权酌情就分期失效的限制作出规定,并可根据署长全权酌情决定的因素和情况,包括但不限于实现某些业绩目标、参加者终止雇用或服务、或参加者死亡或残疾,全部或部分加速或放弃这种限制。 |
(三) |
除第9(c)(iii)条另有规定外,在限制期内,参与者一般享有公司股东就受限制股份所享有的权利。根据署长的酌情决定权和适用的授标协议的规定,参加者可有权获得受限制股份授标的红利或等值红利,这些红利将按照署长根据计划第20条确定的授予条件支付。无限售条件股份的证明书,只可在限制期间届满后,由公司全权酌情交付予参与者,而不会就该等受限制股份予以没收,但署长全权酌情另有决定的除外。 |
(四) |
在限制期内参与者终止雇用或服务时,参与者对受限制股份的权利应在授标协议中规定。 |
第10节。限制性股票单位。
(a) |
一般。受限制股票单位可以单独发行,也可以与根据该计划授予的其他奖励一起发行。获授予受限制股份单位的每名参与者,均须与公司订立一份授标协议,该协议须载有由署长自行决定的条款及条件,其中包括拟授予的受限制股份单位数目、适用于受限制股份单位的限制期(如有的话)、适用于受限制股份单位的业绩目标(如有的话)及受限制股份单位的所有其他条件。如果未达到署长规定的限制、业绩目标和/或条件,参加者应按照赠款条款没收其受限制股票单位。限制性股票单位的规定不必对每个参与者都是相同的。不止一项限制 |
D-13
股票单位奖励可授予同一参与者,并在此项下同时未兑现。根据本计划批出的受限制股份单位,须受本条第10条所列的条款及条件所规限,并须载有署长认为适当并在适用的授标协议内所列的附加条款及条件,但不得与本计划的条款相抵触。
(b) |
限制和条件。根据本条第10款批出的受限制股份单位,须受下列限制和条件,以及署长在批出时或其后在符合守则第409A条的规定下所决定的任何附加限制或条件所规限: |
(一) |
署长可全权酌情就分期失效的限制作出规定,并可根据署长全权酌情决定的因素和情况,包括但不限于实现某些业绩目标、参加者终止雇用或服务、或参加者死亡或残疾,全部或部分加速或放弃这种限制。 |
(二) |
持有限制性股票单位的参与者不享有表决权。根据署长的酌情决定权和适用的授标协议的规定,参加者可有权获得受限制股票单位授标的等值红利,这些红利将按照署长根据计划第20条确定的授予条件支付。这种权利将使持有人有权在每一股限制性股票尚未发行时获得相当于就一股股票支付的所有现金股息的数额。署长可酌情决定,自批出之日起,或只在限制性股票归属后,才可批出等值的股息。 |
(三) |
在限制期内参与者终止雇用或服务时,参与者对受限制股票单位的权利应在授标协议中规定。 |
(c) |
和解。尽管有上述规定,署长仍可酌情决定以现金(或股份与现金的任何组合)结算既得受限制股份单位。 |
第11节。其他基于股票或现金的奖励。
(a) |
署长有权在署长认为符合计划宗旨的情况下,以其他股份奖励或其他现金奖励的形式向参加者颁发奖项。获授予其他股份奖励或其他现金奖励的每名参与者应与公司订立一份奖励协议,其中载有由管理人全权酌情决定的条款和条件,其中应载明将授予的股份数量、适用于奖励的限制期(如有)、适用于奖励的业绩目标(如有)以及奖励的所有其他条件。如果未达到署长规定的限制、业绩目标和/或条件,参加者应丧失其根据赠款条款获得奖励的权利。 |
(b) |
依据根据第11条批出的购买权性质的裁决交付的股份或其他证券或财产,须按署长所决定的时间、方法及形式(包括但不限于股份、其他裁决、票据或其他财产)购买,以支付代价,但须受任何所规定的法团行动规限。 |
第12节。归属
(a) |
每项奖励可能会或可能不会受到归属权、限制期、业绩目标和/或署长可能决定的其他条件的限制。在满足授标协议中规定的条件时,应以全额或分期方式进行授予。归属条件可包括基于服务的条件、基于业绩的条件(包括业绩目标)、署长可能决定的其他条件,或两者的任何组合。授标协议可就某些特定事件的加速归属作出规定。 |
(b) |
除个别授标协议另有规定外,每项授标须在三(3)年期间内授予,其中三分之一(1/3)于授标日期一周年时授予,其余的则于其后每月授予。 |
D-14
(c) |
除非署长另有规定,在任何雇员的无薪休假期间,根据本协议批出的赔偿金的归属将被暂停,并将在雇员按署长所确定的正常时间表返回工作之日恢复;但在此种休假期间暂停归属的时间内,不会授予任何归属信贷。在以下情况下,合资格受助人将不会不再是雇员:(i)公司、雇用附属公司或管理人批准的任何休假,或(ii)公司地点之间或公司或任何附属公司之间的转移。就激励股票期权而言,休假不得超过九十(90)天,除非法律或合同保证在休假期满后重新就业。如果公司或子公司批准的休假期满后再就业没有这种保障,那么在休假第91天后的三(3)个月内,参与者持有的任何激励股票期权将不再被视为激励股票期权,并在联邦税收方面被视为不合格股票期权。 |
(d) |
如果在向参与者授予任何奖励之日之后,参与者在为公司或任何子公司提供服务方面的正常时间投入减少(例如,如果参与者是雇员,并且该雇员的身份从全职雇员变为兼职雇员,则不受限制),署长有权全权酌情决定:(i)相应地减少受该授标的任何部分所规限的股份数目,而该部分预定在时间承诺的更改日期后归属或须予支付;及(ii)代替或连同该等减少,延长适用于该授标的归属或付款时间表。如有任何该等减少,参加者将无权就如此减少或延长的奖状的任何部分。 |
第13节。控制权变更。
(a) |
署长可在适用的授标协议中规定,在参加者因控制权变更而终止雇用或服务时,或在署长在授标协议中可能规定的任何其他事件发生时,授标将加速授予。如公司是合理地相当可能导致控制权变更的协议的一方,则该协议可规定:(i)如公司是存续的法团,则公司继续作出任何裁决;(ii)存续的法团或其母公司或附属公司承担任何裁决;(iii)存续的法团或其母公司或附属公司以同等的裁决取代任何裁决;但条件是,有关期权和股票增值权的任何此类替代应按照《守则》第409A条的要求进行;或(iv)就控制权价格变动(在适用范围内减去行使价格)结算任何裁决,或者,如果行使价格等于或超过控制权价格变动,或者如果管理人确定根据其条款不能合理地授予该裁决,则该裁决应终止并被取消,而无需考虑。 |
(b) |
如果限制性股票、限制性股票单位或其他奖励在控制权发生变更时按照其条款以股份结算,这些股份将有权获得与公司股东因控制权变更交易而持有的股份相同的对价。 |
(c) |
就本第13条而言,“控制权变更价格”系指(i)在控制权变更交易中支付给公司股东的每股价格,或(ii)由管理人确定的控制权变更时股票的公平市场价值。如果在任何此种控制权变更交易中支付的对价包括全部或部分证券或其他非现金对价,则此种证券或其他非现金对价的价值应由管理人善意确定。 |
第14节。修正和终止。
(a) |
管理局或委员会可修订、更改或终止本计划,但不得作出任何修订、更改或终止,而该等修订、更改或终止会不利地改变或损害参加者在未经该参加者事先书面同意而批出的任何奖励下的权利。 |
(b) |
尽管有上述规定,(i)为符合《守则》第422条(如适用的话)的规定、该等股份所买卖的证券交易所的任何规则或其他适用法律的规定,任何修订均须取得公司股东的批准;及(ii)除非根据本计划第5条另有准许,否则在任何适用的证券交易所或交易商间报价系统的规则所规定的范围内,未经股东批准,(A)任何修订或修改均不得 |
D-15
降低任何期权或股票增值权的行使价格,(B)管理人不得取消任何未行使的期权或股票增值权,并以新的期权或股票增值权、另一项奖励或现金取而代之;(C)管理人不得采取任何其他被视为“重新定价”的行为,以适用的证券交易所或交易商间报价系统的股东批准规则为目的。
(c) |
在符合《计划》及《守则》第409A条的条款及条件下,署长可根据《计划》修订、延展或续延未获支付的赔偿金,或接受交出未获支付的赔偿金(以尚未行使的范围为限),并批出新的赔偿金以代替(以尚未行使的范围为限)。 |
第15节。计划资金不足的状况。
该计划旨在构成一个“无资金来源”的激励薪酬计划。公司、董事会或委员会均无须设立任何特别或独立的基金,或分隔任何资产,以确保公司履行计划所订的义务。对于本公司尚未支付的任何款项或尚未转让给任何参与者的股份,本协议所载的任何规定均不得给予任何该等参与者任何高于本公司一般无担保债权人的权利。
第16节。延期付款。
在适用法律允许的范围内,管理人可全权酌情决定,在行使、归属或结算任何裁决的全部或部分时,股份的交付或现金的支付应予推迟。署长还可全权酌情决定在该计划下设立一个或多个方案,以允许选定的参与者有机会选择推迟收到任何此类考虑,包括任何适用的选举程序、此类选举的时间安排、如此推迟的金额、股份或其他考虑的支付机制,以及署长认为对管理任何此类推迟方案可取的其他条款、条件、规则和程序。参与方的延期付款(或署长要求的延期结算或付款)应根据《守则》第409A条(如适用)和任何其他适用法律作出。
第17节。预扣税款。
(a) |
每名参加者须在不迟于就联邦、州和/或地方所得税而将奖励的价值首次列入该参加者的总收入之日,向公司缴付或作出令署长满意的安排,以支付法律或规例规定须就奖励而扣缴的任何联邦、州或地方任何种类的国内或国外税款。公司在本计划下的义务须以作出该等付款或安排为条件,而公司有权在法律许可的范围内,从以其他方式欠该参加者的任何付款中扣除任何该等税款。 |
(b) |
凡依据根据本合同授予的裁决支付现金,公司有权从裁决中扣除足以满足与此相关的联邦、州和地方预扣税款要求的金额。每当根据裁决交付股份时,公司有权要求参与者以现金向公司汇出足以支付任何相关的联邦、州和地方税款(国内或国外)的金额,这些税款将被扣缴并用于纳税义务。经管理人批准,参与者可通过选择公司不交付股份或通过交付已拥有的非限制性股票来满足上述要求,在每种情况下,其价值均等于根据适用法律对参与者适用的交易所需扣留的金额或不超过交易所需收取的最高法定费率的其他较大金额,如果管理人确定的其他较大金额不会导致不利的财务会计处理。这些股份应按其在确定扣缴税额之日的公允市场价值估值。零碎股份应以现金结算。该选择可就依据裁决而交付的全部或任何部分股份作出。本公司亦可采用任何其他方法,在适用法律许可的情况下,取得所需的付款或收益,以履行其对任何裁决的扣缴义务。 |
第18节。计划的自由裁量权性质
根据该计划提供的福利和权利完全是酌情决定的,虽然由公司提供,但不构成定期或定期付款。除非适用的法律另有规定,根据该计划提供的福利和权利
D-16
不得被视为参加者薪金或补偿的一部分,亦不得被视为计算任何遣散费、辞职费、裁员或其他服务终止费、假期、奖金、长期服务奖、补偿金、退休金或退休福利,或任何其他付款、福利或任何种类的权利。除非授标协议另有规定,否则参与人接受授标后,即放弃因任何理由而终止服务而获得补偿或损害赔偿的任何及所有权利,只要该等权利是由本计划或任何授标所产生或可能产生的。
第19节。某些没收。
署长可在授标协议中指明,除适用的授标归属条件外,在发生某些事件时,参加者与授标有关的权利、付款和利益须予减少、取消、没收或补偿。此类事件可能包括但不限于违反授标协议中所载的或以其他方式适用于参与者的任何非竞争、非邀约、保密或其他限制性契约、因故终止参与者的雇用或服务,或参与者有损公司、其任何子公司和/或其任何关联公司的业务或声誉的其他行为。
第20节。股利;股利等价物。
尽管本计划中有任何相反的规定,但只要某项奖励包含在该奖励仍未授予时收取红利或等值红利的权利,该等红利或等值红利将在相关奖励授予的范围内一次累积和支付。
第21节。非美国雇员。
在不修订计划的情况下,署长可根据与计划所指明的条款和条件不同的条款和条件,包括公司或其任何附属公司为遵守或利用任何非美国司法管辖区的法律所规定的优惠税收或其他待遇而通过的任何授标协议或计划的条款,向居住在非美国司法管辖区的合格受益人授予授标,这是署长认为必要或可取的,以促进和促进实现计划的宗旨,为促进上述目的,署长可作出必要或可取的修改、修订、程序、子图等,以符合公司或其附属公司在其经营或有雇员的其他国家或司法管辖区的法律条文。
第22节。裁决的转让。
任何授标的持有人违反本计划或授标协议的规定而出售、转让、抵押、抵押、转让、押记、质押、产权负担、赠与、信托转让(投票或其他方式)或以其他方式处分任何授标或任何协议或承诺作出上述任何一项(每一项均称为“转让”)的任何所谓出售、转让、抵押、抵押、转让、押记、质押、赠与、设定担保权益或留置权,均不有效,除非事先取得管理人的书面同意,而该同意可由管理人自行决定予以批准或拒绝,而不是由意志或由血统和分配的法律。任何声称违反本计划或授标协议而转让授标或其中任何经济利益或权益的行为,从一开始即属无效,并不构成公司的任何义务或责任,而任何声称违反本计划或授标协议而转让任何授标或其中任何经济利益或权益的人,亦无权被承认为该等股份的持有人。除非管理人根据前一句的规定另有决定,期权或股票增值权在参与者的有生之年只能由参与者行使,或者在参与者处于法定残疾期间只能由参与者的监护人或法定代理人行使。在任何情况下,未经管理人事先批准,不得允许参与者将期权或股票增值权转让给第三方金融机构,管理人可自行决定不予批准。
第23节。继续就业或服务。
本计划的采纳,不会赋予任何合资格受助人在公司或其任何附属公司或附属公司(视属何情况而定)继续受雇或服务的权利,亦不会以任何方式干预公司或其任何附属公司或附属公司在任何时间终止任何合资格受助人的受雇或服务的权利。
第24节。生效日期。
(a) |
本计划自2023年董事会和公司股东通过本计划之日(“生效日期”)起生效。 |
D-17
(b) |
除非根据第14条提前终止,本计划应于生效日期十年后的2033年终止。 |
第25节。代码409A。
根据该计划支付的款项和福利的目的是,要么不受《守则》第409A条的限制,要么在受其限制的范围内遵守《守则》第409A条的规定,因此,在允许的最大限度内,该计划的解释和管理应与此种意图一致。除非适用法律另有规定,否则计划中所述在《守则》第409A条所界定的“短期延迟期”内到期的任何付款不应被视为递延补偿。尽管计划中有任何相反的规定,但在为避免《守则》第409A条所规定的加速征税和/或税务处罚所需的范围内,本应在“离职”时向属于“特定雇员”的参加者提供的款额和福利,应在该参加者离职后六(6)个月之日后的第一个营业日支付(或在该参加者死亡时,如果更早的话)。此外,为本计划的目的,根据本计划向参与者支付的每一笔款项或提供的每一笔福利,在符合《守则》第409A条的规定下构成递延补偿,应解释为为为《守则》第409A条的目的而单独确定的付款。本计划或授标协议所载的任何规定,不得解释为对授标的任何特定税务效力的保证。本公司并不保证根据本计划提供的任何奖励将获豁免或符合《守则》第409A条的规定,并且在任何情况下,本公司均不对任何参与者因任何奖励受《守则》第409A条的约束而可能招致的任何税款、罚款、利息或其他费用的任何部分或全部承担法律责任。
第26节。遵守法律。
(a) |
公司以股份或其他代价结算奖励的义务须受(i)所有适用的法律、规则及规例所规限,(ii)政府机构或可接纳股份的适用证券交易所所要求的批准,及(iii)公司不时维持的政策,以符合适用的法律、规则、规例及公司治理规定,包括但不限于有关内幕交易的限制。尽管任何裁决的任何条款或条件相反,公司并无义务根据裁决提出出售或出售任何股份,亦不得提出出售或出售任何股份,除非该等股份已根据《证券法》在证券交易委员会妥善登记出售,或除非公司已收到大律师的意见(如公司已要求该意见),而该意见令公司满意,该等股份可根据该等股份的现有豁免而在没有该等登记的情况下发售或出售,而该等豁免的条款及条件已获完全遵守。本公司没有义务根据《证券法》登记出售根据本计划发售或出售的任何股份。 |
(b) |
根据本计划、适用的授标协议、联邦证券法、证券交易委员会的规则、条例和其他要求、公司证券上市或报价所依据的任何证券交易所或交易商间报价系统以及任何其他适用的联邦、州、地方或非美国法律、规则、条例和其他要求,管理人有权规定,根据本计划发行的所有公司股票或其他证券,均应遵守管理人认为适当的停止转让指令和其他限制,及署长可安排在代表根据本计划发行的公司股份或其他证券的证明书上贴上一个或多个图例,以适当提述该等限制,或可安排根据本计划发行的公司股份或其他证券以簿记形式持有,但须受公司的指示或适当的停止转让令所规限。 |
(c) |
尽管《计划》中有任何相反的规定,但署长保留在根据《计划》授予的任何裁决中添加任何附加条款或规定的权利,这些条款或规定是署长全权酌情认为必要或可取的,以使此类裁决符合裁决所管辖的任何政府实体的法律要求。 |
(d) |
如署长全权酌情决定,法律或合约的限制及/或封锁及/或其他市场考虑将使公司从公开市场收购股份、公司向参与者发行股份、参与者从公司收购股份及/或参与者向公开市场出售股份的行为违法、不可行或不可取,则可取消裁决或其任何部分。如署长决定按照上述规定取消裁决的全部或任何部分, |
D-18
在遵守《守则》第409A条所需的任何限制或削减的规限下,公司须(i)向参与者支付一笔金额,该金额相当于(A)受该奖励规限的股份或其部分被取消的股份的合计公平市价(在适用的行使日期或该等股份本应归属或发行的日期(如适用的话)所超出的部分,超过(B)总行使价(在期权或股票增值权的情况下)或作为发行股份的条件而应支付的任何金额(在任何其他奖励的情况下),且该金额应在该奖励或其部分被取消后尽快交付给参与者,或(ii)在限制性股票、限制性股票单位或其他基于股份的奖励的情况下,向参与者提供一笔现金付款或根据适用于该等限制性股票的归属限制延期归属和交付的股权,受限制股份单位或其他以股份为基础的奖励,或相关股份。
第27节。补偿政策。
本计划及根据本计划发行的所有奖励,包括根据本计划支付的所有金额和根据本计划发行的所有股份,应由公司根据适用的法律和公司政策(无论何时通过)进行削减、补偿、追回或追回,无论此类政策是否旨在满足《多德-弗兰克华尔街改革和消费者保护法》、《萨班斯-奥克斯利法》或其他适用的法律以及任何实施条例和/或上市标准的要求。
第28节。管辖法律。
本计划应受特拉华州法律管辖并按其解释,但不影响该州法律冲突的原则。
第29节。计划文件控制。
本计划和每份授标协议共同构成关于本计划及其标的的全部协议;但如果本计划和该授标协议之间有任何不一致之处,则应由本计划的条款和条件加以控制。
D-19
私人的和保密的 |
2023年3月8日 |
Apeiron Capital Investment Corp.
联邦街175号
875套房
马萨诸塞州波士顿02110
公平意见函
Apeiron Capital Investment Corp.(Apeiron Capital Investment Corp.,简称“Apeiron”)于2022年10月14日与GIO World Health,Ltd.(简称“本公司”)签订了一份意向书(简称“原始协议”)。原始协议的收购对价为100%的GIO World Health普通股,基于2.5亿美元的投资前企业价值。该协议的条款假定交易金额为2.65亿美元,其中包括Apeiron提供的1530万美元现金和2.5亿美元的卖方滚转股本。协议还规定,在交易结束后的五年内,三批盈利股将视股价目标的实现情况而定:第一批1500万股盈利股,第二批1800万股盈利股,第三批2100万股盈利股。
交易的条款和条件在原始协议中有更全面的规定。
Apeiron已聘请EverEdge Global Ltd.(“EverEdge”)作为独立估值专家,目的是从财务角度为Apeiron的股东发布对本次交易公平性的评估(“公平性意见”)。
为了提供这一公平意见,我们进行了必要的分析,并考虑了以下信息:
| ● | 拟议交易的财务条款和条件载于《巴塞尔公约》。 |
| ● | GIO管理层(“管理层”)提供的财务预测; |
| ● | 管理层建议的某些准则上市公司和先例交易具有类似于GIO预期所追求的业务线方面的特性; |
| ● | 其他可公开获得的行业信息(即各种股票分析师报告、宏观经济报告和关于指导公司的公开信息)、从虚拟数据室获得的信息以及从FactSet等数据库获得的相关市场数据; |
| ● | 与管理层就GIO计划的业务线以及与GIO业务计划相关的关键假设和风险进行了确认性讨论,包括某些行业EV/EBITDA倍数、贴现率和营运资本假设(EverEdge将其与独立的行业研究进行了比较,并认为这些假设是合理的); |
| ● | 与管理层就适当的单位经济和与GIO计划的业务线相关的关键指标进行了确认性讨论。 |
| ● | PCAOB独立审计师提交的截至2021年12月31日止年度的GIO World Health财务报告; |
| ● | GIO World Health管理层准备的公司介绍台; |
| ● | GIO World Health公司结构文件,包括私人有限公司注册证书和私人股份有限公司章程范本; |
| ● | Apeiron Capital投资公司SEC表格8-K提交日期为2022年12月21日 |
此外,我们还进行了我们认为有必要的价值计算和财务分析,以便发表以下意见。
使用的主要方法是市场法----作为公平性意见评估基础的公开交易公司准则(GPTC)。这些公开资料是由EverEdge独立获得的。管理层还提供了作为次要比较进行审查并发现与公平意见评估所使用的比较结果相似的比较结果。
我们还完成了收益法——贴现现金流作为二级估值方法,并考察了关键投入的公开业绩和市场交易数据。所执行的分析的更多细节可以在相关的代理声明中找到。
在我们的评估中,我们依赖于GIO World Healthcare提供的信息的正确性和完整性,而没有进行独立验证。我们依赖GIO World Healthcare管理层的保证,即他们不知道任何事实或情况会使此类信息或数据在任何重要方面不准确或具有误导性。关于GIO世界医疗保健预测,GIO告知我们,并假定这些预测是根据反映了GIO世界医疗保健管理层对GIO未来财务业绩的现有最佳估计和善意判断的基础合理编制的。我们没有对GIO的财产或资产进行任何实物检查。我们没有根据任何与破产、无力偿债或类似事项有关的法律评估GIO World Health的偿付能力或公允价值。我们假设交易将按照经修订的意向书(2023年2月1日)中所述的条款完成,而不会在2023年2月1日之后进一步放弃、修改或修订任何重要条款、条件或协议,并且在为交易获得必要的政府、监管和其他批准、同意、放行和豁免的过程中,不会施加任何延迟、限制、限制或条件,包括任何剥离要求或修改或修改,这将对GIO或交易的预期收益产生不利影响。我们不对根据提供给我们的错误或不完整信息得出的结论负责。
在Apeiron公平意见审查委员会发表了一段时间的评论之后,我们的任务于2023年3月8日完成。在此日期之后发生的任何事件或信息均未被考虑。
EverEdge由Apeiron聘请,以提供与交易相关的公平意见,并将收取固定的服务费。EverEdge的费用不取决于交易对价的大小,也不取决于交易是否完成。
我们向Apeiron提供此公平意见,Apeiron在与Apeiron股东就本次交易进行沟通时,只能完整使用本文件。我们在下面发表的意见不应被解释为关于Apeiron股东是否应批准该交易的建议。
公平意见结论
基于EverEdge所做的工作和上述陈述,我们认为,从财务角度来看,在本文件发布之日,拟议的交易对Apeiron的股东是公平的。
你真诚的,

泰勒·卡普森
特许估价师及估价师(CVA # 100150)
董事总经理
EverEdge全球有限公司。
主要审阅者: |
二级审查员: |
Stefan Tan |
凯文·梅斯 |
估值高级经理 |
董事 |
EverEdge全球有限公司。 |
EverEdge全球有限公司。 |
|
如需更多信息,请联系:
EverEdge全球
Tryon街101号套房2700
夏洛特,北卡罗来纳州28280
everedgeglobal.com |
第3页 |
Prospectus中不需要的信息
项目20。董事及高级人员的补偿。
拟议的章程将在业务合并完成后生效,其中规定,我们的所有董事、高级职员、雇员和代理人均有权在DGCL第145条允许的最大限度内获得我们的赔偿。DGCL关于高级职员、董事、雇员和代理人的赔偿的第145条载列如下。
第145节。高级人员、董事、雇员和代理人的赔偿;保险。
| (a) | 任何法团有权就任何曾是或现已是任何受威胁、待决或已完成的诉讼、诉讼或法律程序(不论是民事、刑事、行政或调查诉讼或法律程序)的一方,或因该人是或曾是该法团的董事、高级人员、雇员或代理人,或因该人是或曾是或曾应该法团的要求担任另一法团、合伙企业、合营企业、信托或其他企业的董事、高级人员、雇员或代理人而被威胁成为该诉讼、诉讼或法律程序的一方,向该人作出弥偿,如该人是以诚信行事,并以该人合理地认为符合或不违反法团最佳利益的方式行事,且就任何刑事诉讼或法律程序而言,并无合理的理由相信该人的行为是非法的,则该人就该等诉讼、诉讼或法律程序而实际及合理地招致的费用(包括律师费)、判决、罚款及和解款项。以判决、命令、和解、定罪或根据nolo contendere或其同等人的抗辩而终止任何诉讼、诉讼或法律程序,其本身并不构成一项推定,即该人没有以合理地相信符合或不反对法团最佳利益的方式善意行事,而就任何刑事诉讼或法律程序而言,该人有合理的理由相信该人的行为是非法的。 |
| (b) | 任何法团有权就任何曾是或现为一方的人,或被威胁成为一方的人,作出弥偿,该人是或曾是一方的董事、高级人员、雇员或代理人,或应法团的要求担任另一法团、合伙企业、合营企业的董事、高级人员、雇员或代理人,信托或其他企业就该人就该诉讼或诉讼的抗辩或和解而实际及合理地招致的开支(包括律师费),但如该人以该人合理地相信符合或不反对该法团的最佳利益的方式善意行事,则该人不得就任何申索作出弥偿,发出该人已被判定对法团负有法律责任的事宜或事宜,除非且仅限于衡平法院或提起该诉讼或诉讼的法院应申请而裁定,尽管已就法律责任作出裁决,但鉴于该案件的所有情况,该人公平合理地有权就衡平法院或该等其他法院认为适当的开支获得弥偿。 |
| (c) | 凡任何法团的现任或前任董事或高级人员已就本条(a)及(b)款所提述的任何诉讼、诉讼或法律程序的是非曲直或其他理由而胜诉,或已就其中所提述的任何申索、问题或事宜而胜诉,则该人须获弥偿其就该等诉讼、诉讼或法律程序而实际及合理招致的开支(包括律师费)。 |
| (d) | 根据本条(a)及(b)款作出的任何弥偿(除非由法院下令),须由法团作出,而该法团只须在就具体个案而获授权的情况下,因该人已符合本条(a)及(b)款所列的适用行为标准,而决定在有关情况下对该现任或前任董事、高级人员、雇员或代理人作出弥偿是适当的。就作出上述裁定时身为董事或高级人员的人而言,须作出上述裁定:(1)由并非该诉讼、诉讼或法律程序当事方的董事以多数票作出,即使少于法定人数;或(2)由该等董事以多数票指定的该等董事组成的委员会作出,即使少于法定人数;或(3)如无该等董事,或如该等董事如此指示,则由独立法律顾问以书面意见作出;或(4)由股东作出。 |
| (e) | 高级人员或董事在为任何民事、刑事、行政或调查行动、诉讼或法律程序辩护时所招致的开支(包括律师费),可由法团在收到由该董事或高级人员或代表该董事或高级人员作出的偿还该等款额的承诺后,在该诉讼、诉讼或法律程序的最后处置前支付,但最终须确定该人无权按本条授权获得法团的弥偿。前高级人员及董事或其他雇员及代理人所招致的开支(包括律师费),可按法团认为适当的条款及条件支付。 |
二-1
| (f) | 由本条其他款提供或依据本条其他款批予的补偿及预支开支,不得视为排除寻求补偿或预支开支的人士根据任何附例、协议、股东或无利害关系的董事的投票权或其他权利而可享有的任何其他权利,包括以该人的官方身分采取的行动,以及在担任该职位期间以其他身分采取的行动。根据公司注册证书或附例的规定而产生的补偿或预支费用的权利,不得因作为或不作为的发生而因对该规定的修订而消除或损害,该作为或不作为是寻求补偿或预支费用的民事、刑事、行政或调查行动、诉讼或法律程序的主体,除非在该作为或不作为发生时有效的规定明确授权在该作为或不作为发生后消除或损害。 |
| (g) | 任何法团有权代任何现为或曾为法团的董事、高级人员、雇员或代理人的人,或现为或曾应法团的要求,担任另一法团、合伙企业、合营企业、信托或其他企业的董事、高级人员、雇员或代理人的人,购买和维持保险,以抵偿针对该人而由该人以任何该等身分承担的任何法律责任,或因该人的身分而产生的任何法律责任,而不论该法团是否有权根据本条就该等法律责任向该人作出弥偿。 |
| (h) | 为本条的目的,凡提述“法团”,除所产生的法团外,亦须包括在合并或合并中合并的任何组成法团(包括任何组成法团的任何组成法团),而该组成法团如继续独立存在,本会有权及授权向其董事、高级人员、雇员或代理人作出弥偿,从而使任何现为或曾经是该组成法团的董事、高级人员、雇员或代理人的人,或现为或曾经应该组成法团的要求担任另一法团、合伙企业、合营企业的董事、高级人员、雇员或代理人的人,信托或其他企业,就产生的法团或尚存的法团而言,根据本条所处的地位,与该人就该组成法团而言,如该组成法团继续单独存在,其地位相同。 |
| (一) | 就本条而言,凡提述“其他企业”,即包括雇员福利计划;凡提述“罚款”,即包括就任何雇员福利计划向某人征收的任何消费税;凡提述“应法团的要求服务”,即包括作为法团的董事、高级人员、雇员或代理人,就任何雇员福利计划向该董事、高级人员、雇员或代理人施加责任,或涉及该董事、高级人员、雇员或代理人所提供的服务,雇员福利计划的参与者或受益人;而该人如以合理地相信符合雇员福利计划参与者及受益人的利益的诚意及方式行事,则须当作以本条所提述的“不抵触公司的最佳利益”的方式行事。 |
| (j) | 除非经授权或批准时另有规定,否则由本条提供或依据本条批予的开支的补偿及预支,须继续适用于已不再担任董事、高级人员、雇员或代理人的人,并须符合该人的继承人、遗嘱执行人及管理人的利益。 |
| (k) | 衡平法院在此拥有专属司法管辖权,以审理和裁定根据本条或根据任何法律、协议、股东或无利害关系董事的投票或其他方式提出的所有预支费用或赔偿诉讼。衡平法院可以草率地确定公司预付费用(包括律师费)的义务。 |
根据上述规定或其他规定,我们的董事、高级管理人员和控制人员可能被允许就《证券法》引起的责任进行赔偿,我们已被告知,根据美国证券交易委员会的意见,这种赔偿违反了《证券法》中所述的公共政策,因此是不可执行的。如该董事、高级人员或控制人为成功抗辩任何诉讼、诉讼或法律程序而招致或支付的费用除外,就该等法律责任提出的赔偿要求,则除非其大律师认为该事项已按控制先例解决,向具有适当管辖权的法院提出这样的问题,即法院的这种赔偿是否违反《证券法》中所述的公共政策,并将由这一问题的最终裁决加以管辖。
根据DGCL第102(b)(7)条,我们经修订和重述的公司注册证书规定,任何董事都不对我们或我们的任何股东因违反其作为董事的受托责任而造成的金钱损失承担个人责任,除非DGCL不允许这种责任限制或豁免。我们经修订和重述的公司注册证书的这一规定的效果是消除我们和我们的股东(通过代表我们的股东衍生诉讼)就违反作为董事的受托注意义务向董事追讨金钱损失的权利,包括因疏忽或严重疏忽行为而导致的违约,但受《香港总务委员会条例》第102(b)(7)条限制的除外。然而,本条文并不限制或消除我们的权利或任何股东在违反董事的注意义务时寻求非金钱救济的权利,例如禁制令或撤销。
二2
如果DGCL得到修订,授权采取公司行动,进一步消除或限制董事的责任,那么,根据我们经修订和重述的公司注册证书,我们的董事对我们或我们的股东的责任将被消除或限制在经修订的DGCL授权的最大范围内。任何废除或修订我们经修订及重述的公司注册证书中限制或消除董事责任的条文(不论是由我们的股东或因法律变更而作出的),或采纳与之不一致的任何其他条文,(除非法律另有规定)将只是预期的,除非该等法律修订或变更允许我们在追溯的基础上进一步限制或消除董事的责任。
我们经修订和重述的公司注册证书还规定,我们将在适用法律授权或允许的最大限度内,就所有费用、责任和损失(包括但不限于律师费、判决书、罚款,包括但不限于律师费、判决书、罚款,ERISA的消费税和罚款以及在和解中支付的款项)由任何该等人在任何该等法律程序中合理招致或蒙受。
尽管如此,根据我们经修订及重列的成立法团证明书而有资格获得弥偿的人,只有在该人提起的法律程序获我们的董事会授权的情况下,我们才会就该人提起的法律程序向该人作出弥偿,但强制执行弥偿权利的法律程序除外。
本公司经修订及重列的成立法团证明书所赋予的弥偿权利,是一项合约权利,包括本公司有权在上述任何法律程序作出最终处置前,就其进行辩护或以其他方式参与所招致的开支,但如香港总务委员会要求,本公司高级人员或董事(仅以本公司高级人员或董事的身分)所招致的开支的预支,只有在该高级人员或董事或代表该高级人员或董事向本公司作出承诺后,方可作出,如最终裁定该人无权根据我们的建议宪章或其他方式就该等开支获弥偿,则须偿还所有如此预付的款项。
获得赔偿和预支费用的权利不会被视为排除在任何其他权利之外,我们修订和重述的公司注册证书所涵盖的任何人可能拥有或以后根据法律、我们的拟议章程、我们的拟议章程、协议、股东或无利害关系董事的投票或其他方式获得的任何其他权利。
对经修订和重述的公司注册证书中涉及赔偿权利的条款的任何废除或修订,无论是由我们的股东或法律变更,还是通过与之不一致的任何其他条款,都只会是预期的(除非法律另有规定),除非此类修订或法律变更允许我们在追溯的基础上提供更广泛的赔偿权利,并不会以任何方式减损或不利地影响在该等废除、修订或采纳该等不一致条文时,就在该等废除、修订或采纳该等不一致条文前所发生的任何作为或不作为而存在的任何权利或保障。我们经修订及重列的成立法团证明书,亦会容许我们在法律授权或准许的范围内,以法律授权或准许的方式,向我们经修订及重列的成立法团证明书所特别涵盖的人,作出弥偿及垫付费用。
我们的拟议附例将包括与我们的拟议章程所载的有关预支开支和弥偿权利的条文。此外,我们的附例订明,如我们在一段指定期间内未能足额支付赔偿或预支费用的索偿,则有权提出诉讼。我们的章程也允许我们购买和维持保险,费用由我们承担,以保护我们和/或我们的公司或其他实体、信托或其他企业的任何董事、高级职员、雇员或代理人免受任何费用、责任或损失,无论我们是否有权根据DGCL对此类费用、责任或损失作出赔偿。
任何废除或修订本公司拟议附例中影响弥偿权的条文,不论是由本公司董事会、股东或适用法律的变更,或采纳与之不一致的任何其他条文,(除非法律另有规定)只会是预期的,除非该等法律修订或变更允许本公司在追溯基础上提供更广泛的弥偿权,并不会以任何方式减损或不利地影响在废除或修订或采纳该等不一致条文之前发生的任何作为或不作为而根据该等作为或不作为而存在的任何权利或保障。
三-3
项目21。展品和财务报表附表。
(a) |
以下证物作为本登记声明的一部分提交: |
附件编号 |
|
说明 |
2.1 |
||
2.2 |
||
3.1 |
||
3.2 |
||
3.3 ** |
拟议章程的形式,在企业合并时生效(作为代理声明/招股说明书的附件B)。 |
|
3.4 ** |
拟议附例的格式,于业务合并时生效(作为委托说明书/招股说明书的附件C)。 |
|
4.1 |
||
4.2 |
||
4.3 |
||
4.4 |
Continental Stock Transfer & Trust Company与ACIC之间的认股权证协议。(2) |
|
5.1 ** |
Ellenoff Grossman & Schole LLP的观点。 |
|
8.1 ** |
Ellenoff Grossman & Schole LLP的税务意见。 |
|
10.1 |
||
10.2 |
||
10.3 |
||
10.5 |
||
10.6 |
||
10.7 |
投票协议的形式,日期为2023年3月8日,由Apeiron Capital Investment Corp.、GIO世界健康有限公司及其卖方当事人签署。(1) |
|
10.8 |
锁定期协议的形式,日期为2023年3月8日,由Apeiron Capital Investment Corp.、Apeiron Capital发起人有限责任公司及其卖方当事人签署。(1) |
|
10.9 |
截至2023年3月8日,由Apeiron Capital Investment Corp.、GIO世界健康有限公司及其卖方当事人签署的不竞争协议的形式。(1) |
|
10.10 |
卖方登记权协议的形式,日期为2023年3月8日,由Apeiron Capital Investment Corp.及其卖方当事人签署。(1) |
|
10.11 |
2023年4月5日发给SIA Ventures,LLC的本票。(5) |
|
23.1* |
||
23.2* |
||
23.3* |
Ellenoff Grossman & Schole LLP的同意(作为附件 5.1和附件 8.1的一部分)。 |
|
24.1* |
||
99.1** |
股东代理卡的形式。 |
|
99.2* |
||
99.3* |
||
99.4* |
||
101.印新群岛* |
XBRL实例文档 |
|
101.SCH * |
XBRL分类法扩展模式文档 |
|
101.CAL * |
XBRL分类学扩展计算linkbase文档 |
|
101.DEF * |
XBRL分类学扩展定义linkbase文档 |
|
101.实验室* |
XBRL分类法扩展标签Linkbase文档 |
|
101.预* |
XBRL Taxonomy Extension Presentation Linkbase Document |
|
107 |
二4
+ |
根据条例S-K项目601(a)(5),本附件的某些展品和附表已被省略。ACIC同意应SEC的要求向SEC补充提供任何遗漏的展览或时间表的副本。 |
++ |
表示管理或补偿计划。 |
* |
随函提交。 |
** |
以修订方式提交。 |
*** |
以前提交过。 |
(1) |
本文引用注册人于2023年3月14日提交的表格8-K的当前报告。 |
(2) |
以参考2021年11月12日提交的注册人当前8-K表格报告的方式并入本文。 |
(3) |
本文引用注册人于2022年12月23日提交的表格8-K的当前报告。 |
(4) |
参考注册人于2021年6月24日提交的S-1表格并入本文。 |
(5) |
于2023年5月10日提交的表格8-K上的注册人当前报告,以参考方式并入本文。 |
二-5
项目22。企业
以下签名的注册人在此承诺如下:
(a) |
(1)在作出要约或出售的任何期间内,将本注册声明的生效后修订提交存档: |
(i)列入经修订的1933年《证券法》第10(a)(3)节或《证券法》所要求的任何招股说明书;
(ii)在招股章程中反映在注册说明书(或其生效后的最新修订)生效日期之后出现的任何事实或事件,而这些事实或事件个别地或总体上代表注册说明书所载资料的根本变化。尽管有上述规定,所发行证券数量的任何增加或减少(如果所发行证券的美元总价值不会超过已登记的数额)以及偏离估计最高发行范围的低端或高端的任何情况,可在根据第424(b)条向委员会提交的招股说明书中反映出来,如果总量和价格的变化合计不超过有效登记说明中“注册费的计算”表中所列的最高发行总价的20%;
(三)列入以前未在登记说明中披露的与分配计划有关的任何重要资料,或在登记说明中对此种资料作出的任何重大改动。
(2) |
为确定《证券法》规定的任何赔偿责任,每一项此类生效后的修订均应被视为与其中所提供的证券有关的新的登记声明,届时提供此类证券应被视为首次真诚地提供此类证券。 |
(3) |
本条例旨在藉生效后的修订,将在发售终止时仍未售出的任何正在登记的证券,从登记中除名。 |
(4) |
为确定《证券法》规定的对任何购买者的赔偿责任,根据第424(b)条作为与发行有关的登记声明的一部分而提交的每份招股说明书,除依据第430B条提交的登记声明或依据第430A条提交的招股说明书外,应被视为登记声明的一部分,并应自生效后首次使用之日起列入登记声明。但如属注册说明书的一部分的注册说明书或招股章程内所作的任何陈述,或在作为注册说明书一部分的注册说明书或招股章程内以引用方式并入或当作以引用方式并入的文件内所作的任何陈述,对于在首次使用前有销售合约时间的买方而言,将不会取代或修改在注册说明书或招股章程内所作的任何陈述,而该等陈述是在首次使用日期前的注册说明书或招股章程内所作的,或在紧接该等文件内所作的任何该等陈述。 |
(5) |
为确定根据《证券法》在证券的初始分销中对任何买方的任何赔偿责任,以下签名的登记人承诺,在根据本登记声明由以下签名的登记人首次发行证券时,无论以何种承销方式向买方出售证券,如果证券是通过以下任何通信方式向买方提供或出售的,则以下签名的登记人将是买方的卖方,并将被视为向买方提供或出售此类证券: |
(一) |
根据第424条规则要求提交的与发售有关的任何初步招股说明书或以下签名注册人的招股说明书; |
(二) |
由或代表以下签署人拟备或由以下签署人使用或提述的与发售有关的任何免费书面招股章程; |
(三) |
与发售有关的任何其他免费书面招股章程中载有由或代表以下签名的注册人提供的有关以下签名的注册人或其证券的重要资料的部分;及 |
(四) |
以下签名的注册人向买方发出的任何其他属于要约中的要约的通信。 |
(6) |
被视为第145(c)条所指的承销商的任何人或任何一方在使用作为本登记声明一部分的招股说明书公开重新发售根据本登记的证券之前,发行人承诺,该重新发售招股说明书将包含适用的登记表所要求的关于可能被视为承销商的人重新发售的信息,以及适用表格的其他项目所要求的信息。 |
二六
(7) |
每一份招股说明书:(一)根据前一款提交的,或(二)声称符合《证券法》第10(a)(3)条的要求并用于受第415条规则约束的证券发行的,将作为登记声明修正案的一部分提交,在该修正案生效之前不得使用,为确定《证券法》规定的任何赔偿责任,每一份生效后的修正案应被视为与其中所发行的证券有关的新的登记声明,而该等证券在当时的发售,须视为该等证券的首次真诚发售。 |
(8) |
根据上述规定或其他规定,下列签署人的董事、高级管理人员和控制人员可能被允许就《证券法》引起的赔偿责任进行赔偿,下列签署人已被告知,证券交易委员会认为,这种赔偿违反了《证券法》中所述的公共政策,因此是不可执行的。如该董事、高级人员或控制人就所登记的证券而提出要求赔偿该等法律责任的申索(下列签署人支付下列签署人的董事、高级人员或控制人为成功抗辩任何诉讼、诉讼或法律程序而招致或支付的开支除外),则除非其大律师认为该事项已以控制先例解决,向具有适当管辖权的法院提出这样一个问题,即法院的这种赔偿是否违反了该法案中所述的公共政策,并将由对这一问题的最终裁决加以管辖。 |
(b) |
以下签名的注册人在此承诺,对于根据本表格第4、10(b)、11或13项以引用方式并入招股说明书的信息请求,在收到请求后的一个工作日内作出回应,并以第一类邮件或其他同样迅速的方式发送合并文件。这包括在登记声明生效之日之后直至对请求作出答复之日提交的文件中所载的信息。 |
(c) |
下列签署人在此承诺,以生效后的修订方式,提供与某项交易有关的所有资料,以及其中所涉及的被收购公司,而该等资料在登记声明生效时并不是登记声明的主题,亦不包括在登记声明内。 |
二七
签名
根据1933年《证券法》的要求,登记人已正式安排下列签署人于2023年5月11日在马萨诸塞州玻色森代表登记人签署本登记声明,并获得正式授权。
Apeiron Capital Investment Corp. |
||
签名: |
Joel Shulman |
|
姓名: |
Joel Shulman |
|
职位: |
首席执行官 |
|
授权书
通过这些礼物了解所有人,以下每一位签署人构成并指定Joel Shulman和Grant Grigorian各自单独行事,他或她的真实和合法的律师和代理人,具有完全的替代和重新替代权力,并以他或她的名义、地点和代替,以任何和所有身份在表格S-4上签署本登记声明(包括根据经修订的1933年《证券法》颁布的第462(b)条提交的所有生效前和生效后的修订和登记声明),并将其连同所有证物一起归档,以及与此有关的其他文件,与美国证券交易委员会,授予上述实际代理人和代理人,每个人单独行动,充分的权力和授权去做和执行每一个必要和必要的行为和事情,尽可能充分地达到他或她可能或可能亲自做的所有意图和目的,特此批准并确认任何此类实际代理人和代理人,或他的替代人,可以合法地做或安排做本协议所规定的事情。
根据1933年《证券法》的要求,本登记声明已由下列人士在所示日期签署。
姓名 |
|
职务 |
|
日期 |
Joel Shulman |
董事会主席兼首席执行官 |
2023年5月11日 |
||
Joel Shulman |
(首席执行干事) |
|||
Grant Grigorian |
首席财务官 |
2023年5月11日 |
||
Grant Grigorian |
(首席财务和会计干事) |
|||
Eva Adosoglou |
首席运营官 |
2023年5月11日 |
||
Eva Adosoglou |
||||
Kevin Cramton |
董事 |
2023年5月11日 |
||
Kevin Cramton |
||||
Charles Aggouras |
董事 |
2023年5月11日 |
||
查尔斯·阿古拉斯 |
||||
Jeffrey Mortimer |
董事 |
2023年5月11日 |
||
Jeffrey Mortimer |
二八